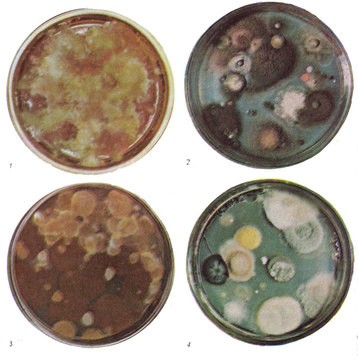
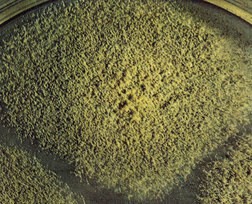

[Настройки текста] [Cбросить фильтры]
[Оглавление]
Всё о грибах
Введение
Грибы — организмы, широко распространенные в природе и встречающиеся в различных, иногда самых неожиданных местах обитания. Они живут в почве и воде, на различных мертвых остатках растений и животных, а таТикунов кже паразитируют на живых организмах. Грибы можно встретить в глубоких темных пещерах и в заоблачных высотах гор, в знойных безводных пустынях, зонах вечной мерзлоты, на болотах, они способны пробиться сквозь бетон и асфальт, а споры их можно обнаружить во всем воздушном пространстве нашей планеты, причем даже в стратосфере, куда они заносятся воздушными потоками. Велика роль грибов в круговороте веществ. Разлагая органические остатки, грибы вместе с бактериями участвуют в почвоообразовании и, в частности, в образовании плодородного слоя почвы — гумуса. Паразитируя на растениях и животных, грибы вызывают у них различные заболевания (стригущий лишай у животных), приносят значительный урон сельскому хозяйству (головня и ржавчина хлебных злаков). Поселяясь на сельскохозяйственных продуктах, сырье и полуфабрикатах, грибы могут стать причиной их порчи и даже интоксикации. Большой вред приносят грибы, повреждая всякого рода материалы и изделия, порче подвержены даже металлические конструкции, не говоря уже об изделиях из дерева, кожи, бумаги и др. Древоразрушающие грибы наносят существенный вред вегетирующим деревьям и деловой древесине, особенно при хранении и сушке. Поражая деревья, они могут стать причиной их преждевременной гибели, поскольку при ветровалах в первую очередь гибнут ослабленные деревья. Человек издавна использует грибы в различных отраслях производства. Виноделие и хлебопечение — древнейшие наши промыслы были бы невозможны, не догадайся человек использовать полезные свойства дрожжевых грибов. Позже грибы стали применять при изготовлении некоторых видов сыров и в других отраслях пищевой промышленности. Первый антибиотик пенициллин был получен из гриба пеницилла, живущего в почве. Сейчас в медицине применяют и другие, более современные антибиотики, например фузидин, тоже изготовленный на основе микроскопических грибов. В настоящее время из грибов создан полу синтетический пенициллин, более дешевый и обладающий лучшими фармакологическими качествами. Ученые не без основания считают, что в фармакологии у грибов огромное будущее. Грибы используют для получения белковых веществ, применяя как дрожжевые грибы, так и некоторые шляпочные, которые культивируют как обычные сельскохозяйственные культуры. Используются грибы и в других производствах, в частности для получения лимонной кислоты, ферментов, витаминов и др. Со временем роль грибов как продуцентов белка для питания людей и для кормления животных будет, по-видимому, возрастать. Грибы играют огромную роль в жизни леса. Часть из них разлагает лесной опад, причем в этом участвуют как микроскопические, так и многие шляпочные грибы. Некоторые грибы образуют микоризу с деревьями, и это очень важно для деревьев. Например, при степном лесоразведении с участием дуба приходилось вносить в почву землю, содержащую грибницу микори-зообразующих грибов, так как без этого деревья гибли. Лес — главное место обитания съедобных дикорастущих грибов, которыми так богата наша страна. Съедобные грибы — хорошее подспорье в пищевом рационе людей. Грибы — загадочные организмы, и ученые все еще не пришли к общему мнению о том, куда они относятся — к растениям или животным. По-видимому, грибы представляют собой самостоятельное царство природы, возникшее независимо от растений и животных. Книга эта задумана как справочник для работников лесного и сельского хозяйства, географов, биологов и специалистов по охране природных ресурсов, однако мы надеемся, что она заинтересует всех любителей живой природы.Место грибов в живом мире
Грибы, так же как растения и животные, постоянные спутники человека, обязательные участники его жизни и деятельности. По-видимому, еще наши далекие предки, с неимоверным трудом добывавшие себе пищу, находя грибы, с любопытством разглядывали их и пробовали использовать как продукт питания. И нетрудно предположить, что понадобилось немало времени и жертв для того, чтобы они смогли отделить съедобные грибы от ядовитых. Мир грибов столь сложен, что люди разгадали некоторые его тайны только с появлением микроскопа
Мир грибов столь сложен, что люди разгадали некоторые его тайны только с появлением микроскопа
Гипотезы о происхождении грибов
Расширяя свое знакомство с грибами, человек сумел сделать их помощниками в таких древнейших своих производствах, как хлебопечение и виноделие, причем удивительно, что в этих случаях использовались свойства самых мелких грибов, которые человек смог увидеть в микроскоп тысячелетия спустя, только в XIX в.! Вопрос о положении грибов в общей системе природы очень давно стал волновать естествоиспытателей. Весьма своеобразная форма грибов, многообразие их видов, исключительная, как казалось на первый взгляд, непоследовательность, неожиданность и часто ничем внешне не объяснимая массовость их появления, отсутствие каких-либо известных до начала XVIII в. способов их размножения не давали ученым древности достаточно серьезных и убедительных оснований для отнесения грибов к одному из известных тогда царств природы: растениям, животным или минералам. Особенно поражали грибы внезапностью своего появления. Поэтому поиски причин этого явления приводили древних исследователей к самым разнообразным предположениям. Появление грибов связывали то с ударом молнии, то с действием росы, то с испарениями гниющих органических веществ и т. д. А когда жизнь опровергла эти предположения, появление грибов относили просто к игре природы. Приписывали грибам и божественное происхождение, что в значительной степени облегчало задачу "исследователей" того времени. Процесс познания природы грибов очень затянулся. В одном из первых немецких травников, относящихся уже к XVI в., о грибах было сказано буквально так: "Грибы называются детьми богов, ибо родятся они без семян, не так, как другие". Естественно, что если одни говорили о божественном происхождении грибов, то их "научные" оппоненты приписывали грибам связь с нечистой силой. В 1727 г. французский ботаник Вейян утверждал, что грибы — это, бесспорно, изобретение дьявола, придуманное для того, чтобы нарушить гармонию остальной природы, смущать и приводить в отчаяние исследователей... Впрочем, надо сказать, что и в более поздние времена некоторые ученые, не умея найти научного объяснения явлениям природы, приписывали их козням "нечистой силы". Однако история изучения грибов знает и научные подходы к проблеме их положения в системе живой природы. Еще в III в. до нашей эры о грибах как о своеобразных растениях упоминалось в трудах "отца ботаники", древнегреческого ученого Теофраста, выделившего четыре ступени, или царства, природы: неорганическое, растения, животные, человек. Великий классификатор растений и животных шведский ученый Карл Линней в ХУШ в. окончательно закрепил принадлежность грибов к царству растений, хотя и не без колебаний, так как ранее он был склонен причислить грибы вместе с полипами к животным. В своем капитальном труде "Система природы", вышедшем в 1735 г., Линней разбил все растения на 24 класса и отнес грибы к последнему из них, в котором объединил под названием тайнобрачных все растения, не имеющие цветков, т. е. споровые. Что же определило отнесение грибов к растениям? Прежде всего способ их питания — поглощение питательных веществ из раствора через клеточную стенку, а не путем заглатывания пищи, как у животных. Кроме того, грибы с растениями роднило наличие жесткой клеточной стенки, размножение спорами и неограниченный рост. По прошествии более чем двух веков со времен Линнея вновь возник вопрос о правомерности включения грибов в царство растений. Дело в том, что изучение с помощью электронного микроскопа строения грибов и применение точных методов биохимии при исследовании их обмена веществ показали, что, помимо растительных, у грибов имеется еще ряд признаков характерных и для животных. С животными грибы сближают полное отсутствие хлорофилла в клетках и неспособность синтезировать органическое вещество из неорганического, образование мочевины в процессе обмена веществ, наличие хитина в клеточной стенке. Отсюда возникло предположение, что грибы возникли еще до того, как среди примитивных первичных живых организмов обособились организмы с чертами животных или растений. Для решения вопроса о положении грибов в системе живого мира важное значение имеет установление их родственных связей с другими организмами. Существовала гипотеза, что грибы произошли от древнейших водорослей, однако при этом не учитывалось, что водоросли — это типичные фотосинтезирующие организмы и, следовательно, закономерно занимают место в царстве растений. По этому признаку грибы с их отдельными чертами животной организации связать с водорослями не удается. Схема эволюции живого мира, где грибы занимают промежуточное положение между животными и растениями
В настоящее время наиболее обоснованно предположение о том, что грибы произошли от бесцветных примитивных одноклеточных жгутиковых организмов, обитающих в воде, — флагеллят, точнее, от их древнейших предков, которые были, вероятно, одними из первых обитателей первичных водоемов нашей планеты и среди которых еще нельзя было выделить ни типично растительных, ни типично животных организмов. Большинство биологов склоняются сейчас к тому, что грибы — это самостоятельное царство живых организмов, существующее наряду с животными и растениями. Эта гипотеза подтверждается и предполагаемым возрастом грибов по палеонтологическим данным. Ископаемые остатки грибов значительно беднее, чем таковые растений и животных. И все же нам известны отпечатки и окаменелости плодовых тел шляпочных грибов и трутовиков, отпечатки пораженных грибами листьев и других органов растений, грибницы в корнях растений (ископаемые микоризы), ископаемые споры, которых встречается особенно много. На основании этих данных предполагается, что грибы появились у самых истоков жизни в древнейшей геологической эре — архейской, около миллиарда лет назад. Именно этим возрастом датируются находки, сделанные в Австралии, где в соответствующих этому возрасту слоях были найдены зеленые водоросли и вместе с ними лишенные хлорофилла организмы, предположительно отнесенные к грибам. Находки на территории нашей страны, в юго-восточной части Якутии, относящиеся к той же эре, но чуть более позднему периоду (около 850 млн. лет назад), подтверждают существование уже достаточно сформированных грибных организмов.
В начале палеозойской эры, следующей за архейской, в кембрийский период (600 млн. лет назад) — в период господства водорослей и морских беспозвоночных животных — грибы уже достаточно сформировались и существовали как сапротрофы на органических веществах и как паразиты растений и животных. В каменноугольный период этой же эры (265 млн. лет назад) грибы достигли расцвета. В верхнекаменноугольных отложениях Англии в клетках корней некоторых ископаемых сосудистых растений были найдены следы грибных гиф, из чего можно заключить, что уже тогда возникло сложное сожительство грибов с растениями — микориза. Исходя из этого, для некоторых групп грибов время их ответвления на общем стволе развития грибов или время их появления как формирующейся отдельной группы грибов можно определить точнее. Например, широко распространенные и всем известные шляпочные грибы в большинстве своем связаны с корнями древесных пород, под которыми растут. Следовательно, вряд ли они могли появиться значительно раньше этих высших цветковых растений, что служит косвенным подтверждением времени появления этой группы грибов. Можно предположить, что, возникнув где-то одновременно с высшими растениями, шляпочные грибы прошли с ними длительную совместную эволюцию, в результате которой гриб и дерево оказались тесно связанными в своем существовании.
Очень древними являются ржавчинные грибы, паразитирующие на многих зеленых растениях, в том числе и на папоротниках — древнейших наземных зеленых обитателях нашей планеты. Споры этих грибов найдены и на ископаемых остатках папоротников, относящихся к каменноугольному периоду.
К реликтовым видам мелового периода мезозойской эры (130 млн. лет назад) относятся, по палеонтологическим данным, такие пустынные виды грибов — близких родственников дождевиков, как подаксис пестичный и баттарея веселковидная, обитающие в настоящее время в основном в Казахстане и Средней Азии. Вероятно, отсутствие необходимости вести борьбу за пищу и место произрастания в таком пустынном месте позволили этим грибам выжить и сохраниться до наших дней.
Схема эволюции живого мира, где грибы занимают промежуточное положение между животными и растениями
В настоящее время наиболее обоснованно предположение о том, что грибы произошли от бесцветных примитивных одноклеточных жгутиковых организмов, обитающих в воде, — флагеллят, точнее, от их древнейших предков, которые были, вероятно, одними из первых обитателей первичных водоемов нашей планеты и среди которых еще нельзя было выделить ни типично растительных, ни типично животных организмов. Большинство биологов склоняются сейчас к тому, что грибы — это самостоятельное царство живых организмов, существующее наряду с животными и растениями. Эта гипотеза подтверждается и предполагаемым возрастом грибов по палеонтологическим данным. Ископаемые остатки грибов значительно беднее, чем таковые растений и животных. И все же нам известны отпечатки и окаменелости плодовых тел шляпочных грибов и трутовиков, отпечатки пораженных грибами листьев и других органов растений, грибницы в корнях растений (ископаемые микоризы), ископаемые споры, которых встречается особенно много. На основании этих данных предполагается, что грибы появились у самых истоков жизни в древнейшей геологической эре — архейской, около миллиарда лет назад. Именно этим возрастом датируются находки, сделанные в Австралии, где в соответствующих этому возрасту слоях были найдены зеленые водоросли и вместе с ними лишенные хлорофилла организмы, предположительно отнесенные к грибам. Находки на территории нашей страны, в юго-восточной части Якутии, относящиеся к той же эре, но чуть более позднему периоду (около 850 млн. лет назад), подтверждают существование уже достаточно сформированных грибных организмов.
В начале палеозойской эры, следующей за архейской, в кембрийский период (600 млн. лет назад) — в период господства водорослей и морских беспозвоночных животных — грибы уже достаточно сформировались и существовали как сапротрофы на органических веществах и как паразиты растений и животных. В каменноугольный период этой же эры (265 млн. лет назад) грибы достигли расцвета. В верхнекаменноугольных отложениях Англии в клетках корней некоторых ископаемых сосудистых растений были найдены следы грибных гиф, из чего можно заключить, что уже тогда возникло сложное сожительство грибов с растениями — микориза. Исходя из этого, для некоторых групп грибов время их ответвления на общем стволе развития грибов или время их появления как формирующейся отдельной группы грибов можно определить точнее. Например, широко распространенные и всем известные шляпочные грибы в большинстве своем связаны с корнями древесных пород, под которыми растут. Следовательно, вряд ли они могли появиться значительно раньше этих высших цветковых растений, что служит косвенным подтверждением времени появления этой группы грибов. Можно предположить, что, возникнув где-то одновременно с высшими растениями, шляпочные грибы прошли с ними длительную совместную эволюцию, в результате которой гриб и дерево оказались тесно связанными в своем существовании.
Очень древними являются ржавчинные грибы, паразитирующие на многих зеленых растениях, в том числе и на папоротниках — древнейших наземных зеленых обитателях нашей планеты. Споры этих грибов найдены и на ископаемых остатках папоротников, относящихся к каменноугольному периоду.
К реликтовым видам мелового периода мезозойской эры (130 млн. лет назад) относятся, по палеонтологическим данным, такие пустынные виды грибов — близких родственников дождевиков, как подаксис пестичный и баттарея веселковидная, обитающие в настоящее время в основном в Казахстане и Средней Азии. Вероятно, отсутствие необходимости вести борьбу за пищу и место произрастания в таком пустынном месте позволили этим грибам выжить и сохраниться до наших дней.
 Пустынные грибы баттарея и подаксис
Полного своего расцвета грибы достигли в третичный период (около 76-25 млн. лет назад) кайнозойской эры, в которую живем и мы. В этот период, судя по ископаемым находкам, уже существовали все основные группы грибов, которые известны сейчас.
Вопрос о месте грибов в сложной системе живого мира еще нельзя считать окончательно решенным. Только дальнейшие исследования ученых различных биологических специальностей — ботаников-систематиков, биохимиков, генетиков и др., вооруженных новейшими методами исследования, позволяющими изучать тончайшие структуры клетки грибов и особенности обмена веществ в ней, дадут окончательный ответ на этот вопрос.
Пустынные грибы баттарея и подаксис
Полного своего расцвета грибы достигли в третичный период (около 76-25 млн. лет назад) кайнозойской эры, в которую живем и мы. В этот период, судя по ископаемым находкам, уже существовали все основные группы грибов, которые известны сейчас.
Вопрос о месте грибов в сложной системе живого мира еще нельзя считать окончательно решенным. Только дальнейшие исследования ученых различных биологических специальностей — ботаников-систематиков, биохимиков, генетиков и др., вооруженных новейшими методами исследования, позволяющими изучать тончайшие структуры клетки грибов и особенности обмена веществ в ней, дадут окончательный ответ на этот вопрос.
История изучения грибов
Научное латинское название "микота" или "мицетес" грибы получили от греческого названия шампиньонов — "микос", которые знали еще древние греки и которые упоминаются в трудах Теофраста (Ш в. до нашей эры). Тогда были известны главным образом крупные съедобные грибы — шампиньоны, сморчки, трюфели — о них и упоминает Теофраст. От слова "микос" наука о грибах получила название микология, хотя в специальной литературе встречается и другое латинское название грибов — "фунги", произошедшее от собственно латинского существительного "фунгус" — гриб. В русском языке грибы назывались "губы". Название "грибы" появилось только в конце XV или начале XVI в. и относилось преимущественно к трубчатым грибам, имеющим выпуклые, горбатые шляпки. Само это слово, как предполагают лингвисты , произошло от древнерусского слова "гърб" (горб). В течение XVI и XVII вв. на Руси существовали оба названия, из которых губы — было более широким, под которым подразумевались все грибы, а грибы — более узким, обозначающим только отдельные их виды. С начала XVIII в. все грибы были объединены под одним названием, которое и вошло в словари русского языка. Однако в некоторых областях СССР (Кировской, Архангельской), в некоторых районах Сибири и Украины до сих пор можно встретить старинное слово губы по отношению к грибам, но и здесь оно сохранилось как народное название трутовиков, живущих на древесине. В рукописном ботаническом словаре, относящемся к концу XVII в., таблица с изображением шляпочных грибов имеет подпись: '...губы, грибы, грузди...'
Грибы издавна употреблялись в пищу, а кроме того, играли роль и в духовной жизни людей. В рукописях монахов, сопровождавших испанских завоевателей в XVI-XVII вв. в походах в Америку и описывавших ныне исчезнувшую культуру древних ацтеков и майя, государства которых находились на территории нынешней Мексики и в Центральной Америке, упоминается о ритуальных обрядах, при которых поедались шляпочные грибы, вызывающие галлюцинации. Изображения этих грибов найдены на стенах храмов майя и в виде ритуальных статуэток, относящихся к первому тысячелетию нашей эры, а также в дошедших до нас немногочисленных рукописных книгах майя, относящихся к первым векам нашей эры. Фантастические изображения человекоподобных мухоморов найдены археологами среди наскальных изображений в Чукотском Заполярье. По-видимому, этот образ был навеян древнейшим североазиатским обычаем поедать мухоморы в качестве галлюциногенного средства, что обычно делали шаманы при религиозных обрядах. Сходство этих изображений и обрядов, их сопровождающих, — одно из доказательств связей народов Азии и Америки и проникновения человека в Северную и Центральную Америку с Азиатского материка. Древние скандинавы, как свидетельствуют летописи, тоже знали об этих свойствах некоторых грибов; перед боем они наедались мухоморов и, приходя от этого в сильное возбуждение, без раздумий бросались в сражение. После Теофраста упоминания о грибах встречаются у ряда авторов классического Рима — Диоскорида, Плиния Старшего, живших в I в. н. э., и некоторых других. Эти ученые дали описание известных им крупных грибов и некоторых их свойств. Диоскорид наряду с описанием съедобных и ядовитых грибов указывал на лечебные свойства лиственничного трутовика и, в частности, на его способность излечивать некоторые желудочно-кишечные заболевания. Таким образом, современная медицинская микология имеет глубокие корни, уходящие в древность.
Плиний Старший в "Естественной истории" сделал попытку первой классификации грибов, разделив их на две группы: съедобные и несъедобные. Такой чисто гастрономический подход к классификации грибов объясняется, по-видимому, тем, что в Древнем Риме грибы уже широко употреблялись в пищу и особенно высоко ценились съедобные качества цезарского гриба из рода мухомора. Его называли "болети" и среди других съедобных грибов считали первым ("фунгорум принцепс"). Об этом грибе неоднократно упоминал Ювенал в своих "Сатирах", относящихся к 1 в. н. э., в частности, он писал: "Бедным друзьям подают другие грибы, неважного сорта, болети — хозяину".
В рукописном ботаническом словаре, относящемся к концу XVII в., таблица с изображением шляпочных грибов имеет подпись: '...губы, грибы, грузди...'
Грибы издавна употреблялись в пищу, а кроме того, играли роль и в духовной жизни людей. В рукописях монахов, сопровождавших испанских завоевателей в XVI-XVII вв. в походах в Америку и описывавших ныне исчезнувшую культуру древних ацтеков и майя, государства которых находились на территории нынешней Мексики и в Центральной Америке, упоминается о ритуальных обрядах, при которых поедались шляпочные грибы, вызывающие галлюцинации. Изображения этих грибов найдены на стенах храмов майя и в виде ритуальных статуэток, относящихся к первому тысячелетию нашей эры, а также в дошедших до нас немногочисленных рукописных книгах майя, относящихся к первым векам нашей эры. Фантастические изображения человекоподобных мухоморов найдены археологами среди наскальных изображений в Чукотском Заполярье. По-видимому, этот образ был навеян древнейшим североазиатским обычаем поедать мухоморы в качестве галлюциногенного средства, что обычно делали шаманы при религиозных обрядах. Сходство этих изображений и обрядов, их сопровождающих, — одно из доказательств связей народов Азии и Америки и проникновения человека в Северную и Центральную Америку с Азиатского материка. Древние скандинавы, как свидетельствуют летописи, тоже знали об этих свойствах некоторых грибов; перед боем они наедались мухоморов и, приходя от этого в сильное возбуждение, без раздумий бросались в сражение. После Теофраста упоминания о грибах встречаются у ряда авторов классического Рима — Диоскорида, Плиния Старшего, живших в I в. н. э., и некоторых других. Эти ученые дали описание известных им крупных грибов и некоторых их свойств. Диоскорид наряду с описанием съедобных и ядовитых грибов указывал на лечебные свойства лиственничного трутовика и, в частности, на его способность излечивать некоторые желудочно-кишечные заболевания. Таким образом, современная медицинская микология имеет глубокие корни, уходящие в древность.
Плиний Старший в "Естественной истории" сделал попытку первой классификации грибов, разделив их на две группы: съедобные и несъедобные. Такой чисто гастрономический подход к классификации грибов объясняется, по-видимому, тем, что в Древнем Риме грибы уже широко употреблялись в пищу и особенно высоко ценились съедобные качества цезарского гриба из рода мухомора. Его называли "болети" и среди других съедобных грибов считали первым ("фунгорум принцепс"). Об этом грибе неоднократно упоминал Ювенал в своих "Сатирах", относящихся к 1 в. н. э., в частности, он писал: "Бедным друзьям подают другие грибы, неважного сорта, болети — хозяину".
 Ритуальные грибообразные статуэтки древних майя и ацтеков из Центральной Америки. Наскальные изображения человекоподобных мухоморов из Чукотского Заполярья
Вероятно, римляне знали и о свойствах ядовитых грибов. Существует, например, предположение, что римский император Клавдий (1 в. н. э.) был отравлен грибами своей женой Агриппиной, матерью будущего императора Нерона. По-видимому, Агриппине не представляло большого труда заменить мужу цезарский гриб "болети" смертельно ядовитой бледной поганкой, относящейся к тому же роду мухоморов.
От средневековья о грибах до нас дошло мало сведений. В то время грибы связывали с "нечистой силой". Появление плодовых тел шляпочных грибов, расположенных по кругу, на лугах и лесных полянах, называли "ведьмиными кольцами" и объясняли тем, что в этих местах ведьмы водили хороводы или устраивали круговые пляски. Проделкам ведьм приписывали и то, что внутри таких колец трава часто бывает чахлой, и при этом утверждали, что скот, поевший этой травы, может погибнуть.
Ритуальные грибообразные статуэтки древних майя и ацтеков из Центральной Америки. Наскальные изображения человекоподобных мухоморов из Чукотского Заполярья
Вероятно, римляне знали и о свойствах ядовитых грибов. Существует, например, предположение, что римский император Клавдий (1 в. н. э.) был отравлен грибами своей женой Агриппиной, матерью будущего императора Нерона. По-видимому, Агриппине не представляло большого труда заменить мужу цезарский гриб "болети" смертельно ядовитой бледной поганкой, относящейся к тому же роду мухоморов.
От средневековья о грибах до нас дошло мало сведений. В то время грибы связывали с "нечистой силой". Появление плодовых тел шляпочных грибов, расположенных по кругу, на лугах и лесных полянах, называли "ведьмиными кольцами" и объясняли тем, что в этих местах ведьмы водили хороводы или устраивали круговые пляски. Проделкам ведьм приписывали и то, что внутри таких колец трава часто бывает чахлой, и при этом утверждали, что скот, поевший этой травы, может погибнуть.
 Гриб-зонтик пестрый из 'Кодекса Клузиуса' конца XVI — начала XVII вв. и на современной фотографии
В эпоху Возрождения вместе с общим подъемом в развитии культуры и науки началось и интенсивное изучение растений. Появились многочисленные "Травники", содержащие подробные описания и изображения различных растений с указаниями их свойств, появились и описания грибов, в основном, правда, опять-таки крупных шляпочных и трутовиков. Выдающийся австрийский ботаник конца XVI — начала XVII в. Клузиус описал более 100 видов грибов. Он снабдил их хорошими для того времени рисунками, составившими "Кодекс Клузиуса", где можно увидеть одни из первых в научной литературе изображения грибов. И все же природа грибов оставалась загадочной не только для ученых эпохи Возрождения, но и вплоть до начала XIX в.
Гриб-зонтик пестрый из 'Кодекса Клузиуса' конца XVI — начала XVII вв. и на современной фотографии
В эпоху Возрождения вместе с общим подъемом в развитии культуры и науки началось и интенсивное изучение растений. Появились многочисленные "Травники", содержащие подробные описания и изображения различных растений с указаниями их свойств, появились и описания грибов, в основном, правда, опять-таки крупных шляпочных и трутовиков. Выдающийся австрийский ботаник конца XVI — начала XVII в. Клузиус описал более 100 видов грибов. Он снабдил их хорошими для того времени рисунками, составившими "Кодекс Клузиуса", где можно увидеть одни из первых в научной литературе изображения грибов. И все же природа грибов оставалась загадочной не только для ученых эпохи Возрождения, но и вплоть до начала XIX в.
 Отдельные виды грибов, например ежевик каралловидные, безошибочно можно определить по рисункам Клузиуса
В 1729 г. итальянский ученый Микели сделал важнейшее открытие: обнаружил у шляпочных грибов споры и правильно истолковал их как "семена", служащие для размножения. Не менее важное открытие принадлежит французскому ботанику Дютроше, который доказал, что шляпочные и другие грибы — это только плоды, образованные нитевидными разветвлениями, скрытыми под землей, т. е. тем, что мы сейчас называем грибницей или мицелием. До открытия Дютроше ботаники называли грибницу "биссус" и считали одним из самостоятельных родов грибов.
Отдельные виды грибов, например ежевик каралловидные, безошибочно можно определить по рисункам Клузиуса
В 1729 г. итальянский ученый Микели сделал важнейшее открытие: обнаружил у шляпочных грибов споры и правильно истолковал их как "семена", служащие для размножения. Не менее важное открытие принадлежит французскому ботанику Дютроше, который доказал, что шляпочные и другие грибы — это только плоды, образованные нитевидными разветвлениями, скрытыми под землей, т. е. тем, что мы сейчас называем грибницей или мицелием. До открытия Дютроше ботаники называли грибницу "биссус" и считали одним из самостоятельных родов грибов.
 Таблица с рисунками грибов из книг П. Маттиоли, изданной в Венеции в 1565 г
До начала XIX в. изучение грибов фактически велось ботаниками попутно с изучением цветковых растений. И это естественно, поскольку прежде всего они обращали внимание на цветковые растения, хорошо знакомые по повседневной жизни. Грибы же описывались ими только крупные, легко заметные невооруженным глазом. В "Травнике" немецкого ботаника X. Бока (1595 г., объем около 500 страниц) грибам посвящается только одна глава, в которой дается краткое описание десятка шляпочных грибов и трутовиков. Ученый пишет о распространении грибов и времени их появления, некоторых биологических, пищевых свойствах, вкусовых качествах и даже способах приготовления. Здесь же можно увидеть и изображения этих грибов.
Таблица с рисунками грибов из книг П. Маттиоли, изданной в Венеции в 1565 г
До начала XIX в. изучение грибов фактически велось ботаниками попутно с изучением цветковых растений. И это естественно, поскольку прежде всего они обращали внимание на цветковые растения, хорошо знакомые по повседневной жизни. Грибы же описывались ими только крупные, легко заметные невооруженным глазом. В "Травнике" немецкого ботаника X. Бока (1595 г., объем около 500 страниц) грибам посвящается только одна глава, в которой дается краткое описание десятка шляпочных грибов и трутовиков. Ученый пишет о распространении грибов и времени их появления, некоторых биологических, пищевых свойствах, вкусовых качествах и даже способах приготовления. Здесь же можно увидеть и изображения этих грибов.
 Рисунок из книги середины XVIII в., где упоминается название 'биссус' по отношению ко многим неизвестным и непонятным в то время грибам
Для более детального изучения грибов необходим был микроскоп, который появился только в начале XVII в. и еще более 100 лет был несовершенен, в силу чего неохотно использовался ботаниками. Некоторые ученые все же пытались изучать грибы микроскопически и делали при этом верные наблюдения, однако, руководствуясь при этом сложившимися представлениями о цветковых растениях, толковали свои наблюдения ошибочно. Например, Микели, обнаруживший у грибов споры, назвал их семенами и даже описал у грибов цветки, на которых эти семена (споры) якобы образуются. Название же споры было предложено немецким ботаником Гедвигом в 1778 г. Микели был выдающимся ученым, который намного глубже своих современников проник в природу грибов. Он наблюдал не только споры, но и их отделение от плодовых тел грибов и прорастание. Но микроскопические исследования прорастания спор и развития грибницы были продолжены лишь спустя столетие после его работ.
Рисунок из книги середины XVIII в., где упоминается название 'биссус' по отношению ко многим неизвестным и непонятным в то время грибам
Для более детального изучения грибов необходим был микроскоп, который появился только в начале XVII в. и еще более 100 лет был несовершенен, в силу чего неохотно использовался ботаниками. Некоторые ученые все же пытались изучать грибы микроскопически и делали при этом верные наблюдения, однако, руководствуясь при этом сложившимися представлениями о цветковых растениях, толковали свои наблюдения ошибочно. Например, Микели, обнаруживший у грибов споры, назвал их семенами и даже описал у грибов цветки, на которых эти семена (споры) якобы образуются. Название же споры было предложено немецким ботаником Гедвигом в 1778 г. Микели был выдающимся ученым, который намного глубже своих современников проник в природу грибов. Он наблюдал не только споры, но и их отделение от плодовых тел грибов и прорастание. Но микроскопические исследования прорастания спор и развития грибницы были продолжены лишь спустя столетие после его работ.
 Рисунок из книги Х. Бока (1595 г.)
Сведения и представления естествоиспытателей о микроскопических грибах, заметных невооруженным глазом только в виде различных налетов и плесеней, были еще более туманны. В первую очередь привлекли к себе внимание паразитные грибы на растениях. Такие болезни, как головня и ржавчина хлебных злаков, так называемая мучнистая роса на листьях винограда, были известны еще древним грекам и упоминались Теофрастом. В связи с развитием земледелия в Древнем Риме ученые стали уделять внимание и даже довольно подробно описывать эти болезни, которые часто вызывали массовые заболевания (эпифитотии) сельскохозяйственных культур. Однако с грибами их, конечно, не связывали, а рассматривали как выделения самих растений под влиянием влажности или других причин.
Рисунок из книги Х. Бока (1595 г.)
Сведения и представления естествоиспытателей о микроскопических грибах, заметных невооруженным глазом только в виде различных налетов и плесеней, были еще более туманны. В первую очередь привлекли к себе внимание паразитные грибы на растениях. Такие болезни, как головня и ржавчина хлебных злаков, так называемая мучнистая роса на листьях винограда, были известны еще древним грекам и упоминались Теофрастом. В связи с развитием земледелия в Древнем Риме ученые стали уделять внимание и даже довольно подробно описывать эти болезни, которые часто вызывали массовые заболевания (эпифитотии) сельскохозяйственных культур. Однако с грибами их, конечно, не связывали, а рассматривали как выделения самих растений под влиянием влажности или других причин.
 Вот так впервые увидели Гук и Мальпиги в микроскоп ржавчинные грибы (середина XVII в.)
В XVII в. микроскописты Гук и Мальпиги наблюдали под микроскопом ржавчинные грибы и изображали их так точно, что по их рисункам и сейчас можно без особого труда определить описанные ими виды. Однако объясняли они появление ржавчинных грибов какими-то видоизменениями самого листа. В 1833 г. в книге Франца Унгера "Сыпи у растений" развивалась подобная теория о паразитных микроскопических грибах. Унгер писал: "Болезненное состояние соков — причина болезней, грибные огранизмы — следствие". И только шведский ботаник Э. Фриз (1794-1878) впервые причислил микроскопических возбудителей болезней растений к грибам, сделав при этом оговорку, что возникают они все-таки из клеток растений, на которых появляются.
Карл Линней в своей "Системе природы" в 1735 г. описал 95 видов грибов, однако, не сумев их классифицировать, определил выделенную им группу как хаос, в котором якобы невозможно найти никакой системы. "Порядок грибов хаос есть..." — писал о них К. Линней.
В начале XIX в. начались более широкие исследования грибов, чему способствовало не только усовершенствование микроскопа, но и то, что грибы оказались причиной болезней многих сельскохозяйственных растений. Учеными было описано множество макро- и микроскопических грибов, но чтобы разобраться в их исключительном многообразии, необходимо было их классифицировать, как это сделал с цветковыми растениями Карл Линней. Эту важнейшую в микологии работу сделали двое ученых: голландский врач X. Г. Персоон и шведский ботаник Э. Фриз. Двухтомный список грибов Персоона, в котором он приводит, кроме описаний видов, и вполне разработанную классификацию грибов, почти 30 лет был единственной полной сводкой грибов, по которой можно было определить тот или иной вид или найти место среди близких видов для вновь открываемых. Описания Персоона настолько точны, что названия многих видов грибов, установленные им, сохранены и до настоящего времени. Примером таких описаний могут служить гриб-баран и плоский трутовик, растущие у оснований стволов и на пнях лиственных пород деревьев, ложнодождевик обыкновенный, обычный на почве в лиственных лесах, многие виды сыроежек, валуй и др.
Э. Фриз написал фундаментальную книгу "Система микологии", которая выходила с 1821 по 1832 г. и где было описано несколько тысяч видов грибов, в том числе и микроскопических, распределенных по отдельным группам. Работы Фриза создали фундамент для последующего развития самостоятельной науки о грибах — микологии.
Вот так впервые увидели Гук и Мальпиги в микроскоп ржавчинные грибы (середина XVII в.)
В XVII в. микроскописты Гук и Мальпиги наблюдали под микроскопом ржавчинные грибы и изображали их так точно, что по их рисункам и сейчас можно без особого труда определить описанные ими виды. Однако объясняли они появление ржавчинных грибов какими-то видоизменениями самого листа. В 1833 г. в книге Франца Унгера "Сыпи у растений" развивалась подобная теория о паразитных микроскопических грибах. Унгер писал: "Болезненное состояние соков — причина болезней, грибные огранизмы — следствие". И только шведский ботаник Э. Фриз (1794-1878) впервые причислил микроскопических возбудителей болезней растений к грибам, сделав при этом оговорку, что возникают они все-таки из клеток растений, на которых появляются.
Карл Линней в своей "Системе природы" в 1735 г. описал 95 видов грибов, однако, не сумев их классифицировать, определил выделенную им группу как хаос, в котором якобы невозможно найти никакой системы. "Порядок грибов хаос есть..." — писал о них К. Линней.
В начале XIX в. начались более широкие исследования грибов, чему способствовало не только усовершенствование микроскопа, но и то, что грибы оказались причиной болезней многих сельскохозяйственных растений. Учеными было описано множество макро- и микроскопических грибов, но чтобы разобраться в их исключительном многообразии, необходимо было их классифицировать, как это сделал с цветковыми растениями Карл Линней. Эту важнейшую в микологии работу сделали двое ученых: голландский врач X. Г. Персоон и шведский ботаник Э. Фриз. Двухтомный список грибов Персоона, в котором он приводит, кроме описаний видов, и вполне разработанную классификацию грибов, почти 30 лет был единственной полной сводкой грибов, по которой можно было определить тот или иной вид или найти место среди близких видов для вновь открываемых. Описания Персоона настолько точны, что названия многих видов грибов, установленные им, сохранены и до настоящего времени. Примером таких описаний могут служить гриб-баран и плоский трутовик, растущие у оснований стволов и на пнях лиственных пород деревьев, ложнодождевик обыкновенный, обычный на почве в лиственных лесах, многие виды сыроежек, валуй и др.
Э. Фриз написал фундаментальную книгу "Система микологии", которая выходила с 1821 по 1832 г. и где было описано несколько тысяч видов грибов, в том числе и микроскопических, распределенных по отдельным группам. Работы Фриза создали фундамент для последующего развития самостоятельной науки о грибах — микологии.
Микология — наука о грибах
В середине XIX в. в микологии наметились новые направления. Кроме изучения форм и строения органов грибов, например плодовых тел, началось интенсивное изучение самих процессов формирования и развития этих органов грибов. Одновременно вместо крупных шляпочных грибов и трутовиков объектами исследований стали преимущественно микроскопические грибы, из которых прежде всего привлекли к себе внимание ученых паразитные грибы, наносившие огромный урон культурным растениям. Становилось очевидным, что люди ждут от микологов практических рекомендаций о методах эффективной борьбы с этим беспощадным губителем сельскохозяйственных культур. В виде 'неизведанной новой земли' изобразили братья Тюлянь грибы на рисунке в своей книге, относящейся к середине XIX в. Спороношение гриба — пикниды выглядят на этом таинственном острове как горы и вулканы; плодовые тела сумчатых грибов с многочисленными ветвистыми отростками образуют лес, а более мелкие спороношения грибов — заросли кустарников
Изучение важнейших паразитных грибов — головневых, ржавчинных, картофельного гриба фитофторы инфестанс и других видоизменилось, приняв наряду с наблюдениями экспериментальный характер, который мог дать исследователям практический выход. Это направление в микологии связано с именами французских ученых братьев Тюлянь и немецкого ученого Антона де Бари, которого по праву называют "отцом микологии". Братья Тюлянь выполнили много исследований разных групп грибов — мучнисторосяных, ржавчинных и др. Особенностью их исследований явилось то, что они обращали внимание не только на готовое строение организма, но и на все его развитие, ставя перед собой задачу проследить за изменением гриба в течение его жизни. Эти ученые установили у грибов явление плеоморфизма, т. е. образования одним видом гриба нескольких различных спороношений в зависимости от стадии его развития. Однако, довольно глубоко познав особенности грибов, они рассматривали их как малоизученную, почти неизвестную область природы.
В виде 'неизведанной новой земли' изобразили братья Тюлянь грибы на рисунке в своей книге, относящейся к середине XIX в. Спороношение гриба — пикниды выглядят на этом таинственном острове как горы и вулканы; плодовые тела сумчатых грибов с многочисленными ветвистыми отростками образуют лес, а более мелкие спороношения грибов — заросли кустарников
Изучение важнейших паразитных грибов — головневых, ржавчинных, картофельного гриба фитофторы инфестанс и других видоизменилось, приняв наряду с наблюдениями экспериментальный характер, который мог дать исследователям практический выход. Это направление в микологии связано с именами французских ученых братьев Тюлянь и немецкого ученого Антона де Бари, которого по праву называют "отцом микологии". Братья Тюлянь выполнили много исследований разных групп грибов — мучнисторосяных, ржавчинных и др. Особенностью их исследований явилось то, что они обращали внимание не только на готовое строение организма, но и на все его развитие, ставя перед собой задачу проследить за изменением гриба в течение его жизни. Эти ученые установили у грибов явление плеоморфизма, т. е. образования одним видом гриба нескольких различных спороношений в зависимости от стадии его развития. Однако, довольно глубоко познав особенности грибов, они рассматривали их как малоизученную, почти неизвестную область природы.
 Еще один рисунок из книги братьев Тюлянь. Среди многообразия грибов изображены те немудренные инструменты, с помощью которых были сделаны многие важные открытия в микологии
Многочисленные экспериментальные исследования этих ученых позволили открыть сложные циклы развития грибов, соединив наконец в единое целое отдельные стадии развития одного и того же вида. Эти исследования паразитных грибов создали научную основу для зарождения фитопатологии — важнейшей отрасли микологии, изучающей грибные болезни растений.
Смелое для того времени предположение, что паразитные грибы — причина, а не следствие, как полагали раньше, болезней растений, высказал Антон де Бари. Он фундаментально изучил развитие возбудителя одной из опаснейших болезней картофеля, вызывающей его массовую гибель, — фитофторы инфестанс, и его исследования стали отправной точкой для поиска способов активной борьбы с грибными болезнями растений. Профессор де Бари и его ученики усовершенствовали также классификацию грибов, значительно приблизив ее к той, которой мы пользуемся сейчас.
Еще один рисунок из книги братьев Тюлянь. Среди многообразия грибов изображены те немудренные инструменты, с помощью которых были сделаны многие важные открытия в микологии
Многочисленные экспериментальные исследования этих ученых позволили открыть сложные циклы развития грибов, соединив наконец в единое целое отдельные стадии развития одного и того же вида. Эти исследования паразитных грибов создали научную основу для зарождения фитопатологии — важнейшей отрасли микологии, изучающей грибные болезни растений.
Смелое для того времени предположение, что паразитные грибы — причина, а не следствие, как полагали раньше, болезней растений, высказал Антон де Бари. Он фундаментально изучил развитие возбудителя одной из опаснейших болезней картофеля, вызывающей его массовую гибель, — фитофторы инфестанс, и его исследования стали отправной точкой для поиска способов активной борьбы с грибными болезнями растений. Профессор де Бари и его ученики усовершенствовали также классификацию грибов, значительно приблизив ее к той, которой мы пользуемся сейчас.
 Так выглядят в современном электронном сканирующем микроскопе спороносный слой шапочного пластинчатого гриба при увеличении в 8 тыс. раз, увиденный с такими подробностями только в 70-е годы текущего столетия
Особое место занимает работа итальянского миколога П. А. Саккардо, который с 1882 по 1931 г. выпустил 25-томную работу, содержащую описания на латинском языке всех известных в то время видов грибов (около 80 тыс.). Эта сводка и сейчас является необходимым пособием в работе микологов.
В конце XIX в. началась дифференциация микологии на различные отрасли, связанные, с одной стороны, с возросшими потребностями практической деятельности людей и, с другой — с усовершенствованием самих методов исследований, которые позволяли не только глубже изучать строение и развитие самого организма (детали строения клетки, особенности ее роста и т. д.), но и проследить результаты деятельности этого организма: его влияние на окружающую среду, изменения, которые он в ней производит при росте и развитии.
Развитие микологии в России связано с именем выдающегося ученого Михаила Степановича Воронина (1838-1903), которого с полным правом считают отцом русской микологии. М. С. Воронин внес серьезный вклад в изучение циклов развития ряда грибов, впервые обнаружил ловчие кольца на мицелии хищных грибов. Его исследования возбудителя килы капусты, ржавчины подсолнечника и возбудителя белой гнили ряда овощей актуальны и в настоящее время. Учеником и продолжателем работ Воронина стал выдающийся миколог, исследователь циклов развития многих грибов академик С. Г. Навашин, который был известным микроскопистом и исследователем внутриклеточных структур грибов.
Особое место в развитии отечественной микологии занимает А. А. Ячевский (1863-1932), который был не только крупным исследователем в области микологии и фитопатологии, но и талантливым популяризатором и организатором науки. По его инициативе в 1902 г. при Петербургском ботаническом саде была создана центральная фитопатологическая станция, а в 1907 г. — бюро по микологии и фитопатологии сельскохозяйственного ученого комитета, взявшие на себя координацию научно-исследовательских работ по изучению грибов.
Фундаментальный труд А. А. Ячевского "Основы микологии", вышедший уже после его смерти, в 1933 г., не потерял своего значения и сейчас.
Развитие советской микологии связано также с именами выдающихся микологов Н. Н. Воронихина, составившего справочник по грибным болезням сельскохозяйственных растений, В. А. Траншеля, исследователя ржавчинных грибов, А. С. Бондарцева, создавшего самую полную монографию о трутовых грибах, и Л. И. Курсанова, автора первого фундаментального учебника по микологии и основателя кафедры низших растений Московского государственного университета, а также Н. А. Наумова, проводившего широкие и важные исследования в различных областях микологии и фитопатологии.
Двадцатые годы XX в. ознаменовались бурным развитием многих отраслей знаний, в том числе и микологии. К классической микологии, занимающейся описанием и классификацией грибов, прибавилась физиология, биохимия и генетика грибов, почвенная микология, изучающая роль грибов в почвообразовательном процессе, и т. д. Величайшим событием в области микологии стало открытие в 1929 г. английским врачом-микробиологом Александером Флемингом антибиотика пенициллина — вещества, подавляющего развитие некоторых болезнетворных бактерий.
В настоящее время микология стала очень многогранной наукой и ее развитие идет по нескольким направлениям. Грибами — возбудителями болезней у людей и животных занимается медицинская микология. Открыты грибы и бактерии, разрушающие, особенно сильно в условиях повышенной влажности, древесину, книги, картины, фрески и другие произведения искусства, лаковые покрытия, оптические приборы и т. д. В борьбу с этими биоповреждениями включились не только микологи, но и микробиологи, химики. Их совместными усилиями был обнаружен механизм воздействия грибов и бактерий на различные предметы и материалы и подобраны химические вещества, препятствующие их развитию.
Важное направление в микологии — поиск нового сырья для микробиологической промышленности. Здесь наметилось несколько направлений. Одно из них — поиски среди грибов источников (продуцентов) новых антибиотиков, ферментов, ростовых -веществ. Были найдены грибы из некоторых родов плесневых и из рода навозников, которые выделяют активный фермент целлюлазу, необходимую для переработки сырья в бумажной промышленности, годную для приготовления грубых кормов и разрушения бумажных отходов. Микробиологическим методом с помощью микроскопических грибов получают фермент пектиназу, используемую для улучшения качества фруктовых соков, и амилазу, применяемую для гидролиза крахмала. Плесневый гриб аспергиллюс нигер используется для получения лимонной кислоты. А совсем недавно арсенал грибов-продуцентов пополнила сыроежка, из которой получен фермент руссулин, нашедший широкое применение при изготовлении целого ряда различных, особенно твердых, сыров, заменив дефицитный препарат реннин, или сычужный фермент, получаемый из желудков телят. В перспективе намечается использование руссулина и как лекарственного препарата, и в этом направлении сейчас ведутся широкие исследования.
Многие грибы паразитируют на насекомых, вызывая их гибель. На этой основе создан препарат боверин, в состав которого входит микроскопический гриб боверия бассиана. Этот препарат был широко применен на Украине для борьбы с колорадским жуком — одним из опаснейших вредителей картофеля. Микробиологическая промышленность продолжает развиваться.
Одно из направлений микологии — изучение условий, в которых грибы-продуценты будут давать наибольшее количество активного вещества. В этих исследованиях серьезное значение приобретает также селекция продуцентов с целью получения все более активных их форм. Отселекционированные формы гриба пеницилла, например, в 100 раз активнее, чем природные. Сейчас микология располагает большим арсеналом средств, среди которых — использование мутагенных факторов (химических веществ, ультрафиолетовых лучей, радиоактивных веществ и т. д.), вызывающих наследственные изменения организма — мутации.
Естественно, что ни одно из направлений современной микологии не способно успешно развиваться без точного знания самого организма гриба, его места в системе грибов, часто определяющего его свойства. Отсюда еще одно важное направление исследований — изучение самих грибов, поскольку далеко не все виды их открыты и изучены. Ежегодно учеными разных стран описываются десятки новых грибов. Постоянно совершенствуется и их система.
Современная систематика, являющаяся компасом в сложном мире грибов, вооружена самыми современными электронно-микроскопическими, физиолого-биохимическими и математическими методами, которые дают огромные возможности для усовершенствования систематики грибов, установления эволюционных и филогенетических (родственных) связей между отдельными их группами.
Так выглядят в современном электронном сканирующем микроскопе спороносный слой шапочного пластинчатого гриба при увеличении в 8 тыс. раз, увиденный с такими подробностями только в 70-е годы текущего столетия
Особое место занимает работа итальянского миколога П. А. Саккардо, который с 1882 по 1931 г. выпустил 25-томную работу, содержащую описания на латинском языке всех известных в то время видов грибов (около 80 тыс.). Эта сводка и сейчас является необходимым пособием в работе микологов.
В конце XIX в. началась дифференциация микологии на различные отрасли, связанные, с одной стороны, с возросшими потребностями практической деятельности людей и, с другой — с усовершенствованием самих методов исследований, которые позволяли не только глубже изучать строение и развитие самого организма (детали строения клетки, особенности ее роста и т. д.), но и проследить результаты деятельности этого организма: его влияние на окружающую среду, изменения, которые он в ней производит при росте и развитии.
Развитие микологии в России связано с именем выдающегося ученого Михаила Степановича Воронина (1838-1903), которого с полным правом считают отцом русской микологии. М. С. Воронин внес серьезный вклад в изучение циклов развития ряда грибов, впервые обнаружил ловчие кольца на мицелии хищных грибов. Его исследования возбудителя килы капусты, ржавчины подсолнечника и возбудителя белой гнили ряда овощей актуальны и в настоящее время. Учеником и продолжателем работ Воронина стал выдающийся миколог, исследователь циклов развития многих грибов академик С. Г. Навашин, который был известным микроскопистом и исследователем внутриклеточных структур грибов.
Особое место в развитии отечественной микологии занимает А. А. Ячевский (1863-1932), который был не только крупным исследователем в области микологии и фитопатологии, но и талантливым популяризатором и организатором науки. По его инициативе в 1902 г. при Петербургском ботаническом саде была создана центральная фитопатологическая станция, а в 1907 г. — бюро по микологии и фитопатологии сельскохозяйственного ученого комитета, взявшие на себя координацию научно-исследовательских работ по изучению грибов.
Фундаментальный труд А. А. Ячевского "Основы микологии", вышедший уже после его смерти, в 1933 г., не потерял своего значения и сейчас.
Развитие советской микологии связано также с именами выдающихся микологов Н. Н. Воронихина, составившего справочник по грибным болезням сельскохозяйственных растений, В. А. Траншеля, исследователя ржавчинных грибов, А. С. Бондарцева, создавшего самую полную монографию о трутовых грибах, и Л. И. Курсанова, автора первого фундаментального учебника по микологии и основателя кафедры низших растений Московского государственного университета, а также Н. А. Наумова, проводившего широкие и важные исследования в различных областях микологии и фитопатологии.
Двадцатые годы XX в. ознаменовались бурным развитием многих отраслей знаний, в том числе и микологии. К классической микологии, занимающейся описанием и классификацией грибов, прибавилась физиология, биохимия и генетика грибов, почвенная микология, изучающая роль грибов в почвообразовательном процессе, и т. д. Величайшим событием в области микологии стало открытие в 1929 г. английским врачом-микробиологом Александером Флемингом антибиотика пенициллина — вещества, подавляющего развитие некоторых болезнетворных бактерий.
В настоящее время микология стала очень многогранной наукой и ее развитие идет по нескольким направлениям. Грибами — возбудителями болезней у людей и животных занимается медицинская микология. Открыты грибы и бактерии, разрушающие, особенно сильно в условиях повышенной влажности, древесину, книги, картины, фрески и другие произведения искусства, лаковые покрытия, оптические приборы и т. д. В борьбу с этими биоповреждениями включились не только микологи, но и микробиологи, химики. Их совместными усилиями был обнаружен механизм воздействия грибов и бактерий на различные предметы и материалы и подобраны химические вещества, препятствующие их развитию.
Важное направление в микологии — поиск нового сырья для микробиологической промышленности. Здесь наметилось несколько направлений. Одно из них — поиски среди грибов источников (продуцентов) новых антибиотиков, ферментов, ростовых -веществ. Были найдены грибы из некоторых родов плесневых и из рода навозников, которые выделяют активный фермент целлюлазу, необходимую для переработки сырья в бумажной промышленности, годную для приготовления грубых кормов и разрушения бумажных отходов. Микробиологическим методом с помощью микроскопических грибов получают фермент пектиназу, используемую для улучшения качества фруктовых соков, и амилазу, применяемую для гидролиза крахмала. Плесневый гриб аспергиллюс нигер используется для получения лимонной кислоты. А совсем недавно арсенал грибов-продуцентов пополнила сыроежка, из которой получен фермент руссулин, нашедший широкое применение при изготовлении целого ряда различных, особенно твердых, сыров, заменив дефицитный препарат реннин, или сычужный фермент, получаемый из желудков телят. В перспективе намечается использование руссулина и как лекарственного препарата, и в этом направлении сейчас ведутся широкие исследования.
Многие грибы паразитируют на насекомых, вызывая их гибель. На этой основе создан препарат боверин, в состав которого входит микроскопический гриб боверия бассиана. Этот препарат был широко применен на Украине для борьбы с колорадским жуком — одним из опаснейших вредителей картофеля. Микробиологическая промышленность продолжает развиваться.
Одно из направлений микологии — изучение условий, в которых грибы-продуценты будут давать наибольшее количество активного вещества. В этих исследованиях серьезное значение приобретает также селекция продуцентов с целью получения все более активных их форм. Отселекционированные формы гриба пеницилла, например, в 100 раз активнее, чем природные. Сейчас микология располагает большим арсеналом средств, среди которых — использование мутагенных факторов (химических веществ, ультрафиолетовых лучей, радиоактивных веществ и т. д.), вызывающих наследственные изменения организма — мутации.
Естественно, что ни одно из направлений современной микологии не способно успешно развиваться без точного знания самого организма гриба, его места в системе грибов, часто определяющего его свойства. Отсюда еще одно важное направление исследований — изучение самих грибов, поскольку далеко не все виды их открыты и изучены. Ежегодно учеными разных стран описываются десятки новых грибов. Постоянно совершенствуется и их система.
Современная систематика, являющаяся компасом в сложном мире грибов, вооружена самыми современными электронно-микроскопическими, физиолого-биохимическими и математическими методами, которые дают огромные возможности для усовершенствования систематики грибов, установления эволюционных и филогенетических (родственных) связей между отдельными их группами.
Строение, биология и классификация грибов
Многообразие форм
 Грибы удивляют нас богатством и необычайностью своей формы, разнообразием строения
Сейчас грибов насчитывается около 100 тыс. видов, причем некоторые микологи предполагают, что число их значительно выше — 250-300 тыс. (для сравнения: число видов растений — около 500 тыс., в том числе цветковых — до 250 тыс., а число видов животных — около 1 млн.). Грибы можно встретить практически по всей территории земного шара, где вообще есть органическое вещество и возможна жизнь гетеротрофных (питающихся готовым органическим веществом) организмов, к которым они принадлежат, — от полярных районов до тропиков, в высокогорьях и в пустынях, в самых разнообразных водоемах. В огромных количествах грибы населяют почву и лесную подстилку, обитают на растениях, животных других грибах и их остатках, на пищевых продуктах, различных материалах и промышленных изделиях и т. д. Лишайники, представляющие собой комплексы, в состав которых входят гриб и водоросль, находящиеся между собой в состоянии динамического равновесия, способны поселяться даже на голых скалах и камнях. Объединение двух организмов в таком симбиотическом комплексе оказалось настолько благоприятным для обоих, что в процессе эволюции образовались такие не похожие на грибы формы, что некоторые ученые рассматривают лишайники как самостоятельную группу организмов. Водоросль, входящая в состав лишайника, способна к фотосинтезу и обеспечивает и себя и гриб органическими веществами, гриб же защищает клетки водоросли от неблагоприятных внешних воздействий и доставляет в них воду и минеральные соединения. Поэтому лишайники способны поселяться там, где не могут обитать другие организмы и, ускоряя выветривание и разрушение горных пород, создают условия для развития растений. Часто лишайники называют "пионерами растительности".
Грибы удивляют нас богатством и необычайностью своей формы, разнообразием строения
Сейчас грибов насчитывается около 100 тыс. видов, причем некоторые микологи предполагают, что число их значительно выше — 250-300 тыс. (для сравнения: число видов растений — около 500 тыс., в том числе цветковых — до 250 тыс., а число видов животных — около 1 млн.). Грибы можно встретить практически по всей территории земного шара, где вообще есть органическое вещество и возможна жизнь гетеротрофных (питающихся готовым органическим веществом) организмов, к которым они принадлежат, — от полярных районов до тропиков, в высокогорьях и в пустынях, в самых разнообразных водоемах. В огромных количествах грибы населяют почву и лесную подстилку, обитают на растениях, животных других грибах и их остатках, на пищевых продуктах, различных материалах и промышленных изделиях и т. д. Лишайники, представляющие собой комплексы, в состав которых входят гриб и водоросль, находящиеся между собой в состоянии динамического равновесия, способны поселяться даже на голых скалах и камнях. Объединение двух организмов в таком симбиотическом комплексе оказалось настолько благоприятным для обоих, что в процессе эволюции образовались такие не похожие на грибы формы, что некоторые ученые рассматривают лишайники как самостоятельную группу организмов. Водоросль, входящая в состав лишайника, способна к фотосинтезу и обеспечивает и себя и гриб органическими веществами, гриб же защищает клетки водоросли от неблагоприятных внешних воздействий и доставляет в них воду и минеральные соединения. Поэтому лишайники способны поселяться там, где не могут обитать другие организмы и, ускоряя выветривание и разрушение горных пород, создают условия для развития растений. Часто лишайники называют "пионерами растительности".
 Поперечный разрез через веточку кустистого лишайника, на котором хорошо видны клетки водоросли между гифами гриба
Широкая экологическая амплитуда, характерная для грибов, определяется морфологическим и функциональным разнообразием, их малочисленными адаптациями (приспособлениями) к самым разнообразным условиям среды, возникшими в процессе эволюции этой группы. Мы встречаем среди них как одноклеточные организмы, например дрожжи или некоторые наиболее примитивные грибы, так и в подавляющем большинстве случаев организмы многоклеточные, нередко отличающиеся довольно сложным строением.
Поперечный разрез через веточку кустистого лишайника, на котором хорошо видны клетки водоросли между гифами гриба
Широкая экологическая амплитуда, характерная для грибов, определяется морфологическим и функциональным разнообразием, их малочисленными адаптациями (приспособлениями) к самым разнообразным условиям среды, возникшими в процессе эволюции этой группы. Мы встречаем среди них как одноклеточные организмы, например дрожжи или некоторые наиболее примитивные грибы, так и в подавляющем большинстве случаев организмы многоклеточные, нередко отличающиеся довольно сложным строением.
 Напочвенные лишайники пельтигера и кладония
Грибы окружают нас везде, но далеко не всегда мы можем видеть их без помощи специальных оптических приборов — микроскопа или сильной лупы. Большинство грибов имеет микроскопические размеры, и в природе, воде, почве, растительных остатках, на живых растениях и животных и т. п. их часто нельзя обнаружить невооруженным глазом. Мы замечаем их только как мелкие дернинки или налеты различной окраски или чаще видим результаты их деятельности, например патологические изменения у растений и животных, разрушение различных материалов и изделий. Примером могут служить ржавчинные, головневые и мучнисто-росяные грибы, получившие свои названия из-за характерного вида поражения ими растений, покрытых ржавыми пятнами спороношений гриба (ржавчина), как бы обугленных или покрытых сажей (головня), или покрытых мучнистым налетом (мучнистая роса). Очень часто грибы образуют плесени самой разнообразной окраски — серые*, черные, зеленые, розовые и др. — на пищевых продуктах, овощах и фруктах при хранении, на зерне, бумаге и других целлюлозосодержащих материалах, тканях, пластмассах, произведениях искусства (на красочном слое картин, деревянной скульптуре и т. п.), на приборах, топливе и многих других материалах и изделиях.
Напочвенные лишайники пельтигера и кладония
Грибы окружают нас везде, но далеко не всегда мы можем видеть их без помощи специальных оптических приборов — микроскопа или сильной лупы. Большинство грибов имеет микроскопические размеры, и в природе, воде, почве, растительных остатках, на живых растениях и животных и т. п. их часто нельзя обнаружить невооруженным глазом. Мы замечаем их только как мелкие дернинки или налеты различной окраски или чаще видим результаты их деятельности, например патологические изменения у растений и животных, разрушение различных материалов и изделий. Примером могут служить ржавчинные, головневые и мучнисто-росяные грибы, получившие свои названия из-за характерного вида поражения ими растений, покрытых ржавыми пятнами спороношений гриба (ржавчина), как бы обугленных или покрытых сажей (головня), или покрытых мучнистым налетом (мучнистая роса). Очень часто грибы образуют плесени самой разнообразной окраски — серые*, черные, зеленые, розовые и др. — на пищевых продуктах, овощах и фруктах при хранении, на зерне, бумаге и других целлюлозосодержащих материалах, тканях, пластмассах, произведениях искусства (на красочном слое картин, деревянной скульптуре и т. п.), на приборах, топливе и многих других материалах и изделиях.
 Нередко можно встретить в наших лесах гриб-зонтик высотой 40 см со шляпкой размером с тарелку и мелкие грибки негниючники с тонкими нитевидными ножками и шляпками не более 0,5 см
Группу грибов, имеющих микроскопические размеры, часто называют микромицетами в отличие от макромицетов — грибов с достаточно крупными, хорошо заметными невооруженным глазом плодовыми телами. Говоря грибы, часто имеют в виду именно эту группу, а точнее — плодовые тела макромицетов. Крупные плодовые тела их имеют самую разнообразную форму, окраску и консистенцию. Среди них всем хорошо известны шляпочные грибы — белые, подосиновики, подберезовики, сыроежки, рядовки, мухоморы и многие другие.
Однако так называемые шляпочные грибы — только один из многочисленных типов плодовых тел макромицетов. У грибов, обитающих на древесине, часто можно встретить боковую шляпку, лишенную ножки, или шляпку со слаборазвитой ножкой, например у вешенки. Очень разнообразны плодовые тела трутовиков. Копытообразные твердые плодовые тела имеют настоящий и окаймленный трутовики; подушкообразные, мягкие в молодом возрасте — березовая губка; расположенные черепитчатыми группами, тонкие — кориолус многоцветный, стереум жестковолосистый; распростертые, как бы обволакивающие субстрат — флебия гигантская. У некоторых трутовиков основание плодового тела вытягивается в более или менее длинную ножку, например у лакированного трутовика. Размеры плодовых тел у трутовиков, как и у шляпочных грибов, колеблются в широких пределах — от гигантских, размером до 0,5-1 м (плоский трутовик, настоящий трутовик и некоторые другие), до крошечных, не превышающих в диаметре 0,5-1 см.
На древесине и почве в лесу можно видеть и макромицеты необычной формы, внешне иногда совершенно непохожие на грибы. Например, гриб-баран, или разветвленный трутовик, выглядит как большой букет из многочисленных (до 200 и более) шляпочных грибов, расположенных на сильно разветвленной ножке, а гериций, или ежевик коралловидный, получил свое название за сходство его обильно разветвленного, покрытого многочисленными шипиками белого с кремовым или розоватым оттенком плодового тела с кораллом. В лесу часто встречаются и многочисленные рогатики, плодовые телакоторых имеют булавовидную форму или выглядят как обильно разветвленные кустики.
Большим многообразием отличаются плодовые тела гастеромицетов, или нутревиков, получивших такое название потому, что споры у них образуются внутри плодового тела, одетого до их созревания плотной оболочкой. Среди них широко распространенные в наших лесах дождевики с шаровидными или грушевидными плодовыми телами, покрытыми часто шипиками или чешуйками, и лангермания гигантская — один из наиболее крупных грибов, плодовое тело которого может достигать диаметра 70-100 см и массы более 12 кг. У веселки обыкновенной и диктиофоры сдвоенной плодовые тела имеют вид складчатой темно-зеленой или оливковой слизистой шляпки, высоко поднятой на белой губчатой ножке — рецептакуле, а у последней из них от основания шляпки на ножку спускается еще длинная сетчатая ажурная "юбочка", за что этот гриб иногда называют "дама с вуалью". Плодовые тела гнездовок вообще не похожи на грибы, а скорее напоминают крошечные, диаметром около 1 см, птичьи гнезда с яйцами. Особенно разнообразны тропические и субтропические гастеромицеты, получившие еще в прошлом веке название "грибы-цветы" за необычайное разнообразие форм и яркость окраски. Это решеточники, цветохвостники и многие другие. В нашей стране некоторые из них встречаются в Закавказье, а иногда с почвой или посадочным материалом попадают в оранжереи и ботанические сады разных районов.
Нередко можно встретить в наших лесах гриб-зонтик высотой 40 см со шляпкой размером с тарелку и мелкие грибки негниючники с тонкими нитевидными ножками и шляпками не более 0,5 см
Группу грибов, имеющих микроскопические размеры, часто называют микромицетами в отличие от макромицетов — грибов с достаточно крупными, хорошо заметными невооруженным глазом плодовыми телами. Говоря грибы, часто имеют в виду именно эту группу, а точнее — плодовые тела макромицетов. Крупные плодовые тела их имеют самую разнообразную форму, окраску и консистенцию. Среди них всем хорошо известны шляпочные грибы — белые, подосиновики, подберезовики, сыроежки, рядовки, мухоморы и многие другие.
Однако так называемые шляпочные грибы — только один из многочисленных типов плодовых тел макромицетов. У грибов, обитающих на древесине, часто можно встретить боковую шляпку, лишенную ножки, или шляпку со слаборазвитой ножкой, например у вешенки. Очень разнообразны плодовые тела трутовиков. Копытообразные твердые плодовые тела имеют настоящий и окаймленный трутовики; подушкообразные, мягкие в молодом возрасте — березовая губка; расположенные черепитчатыми группами, тонкие — кориолус многоцветный, стереум жестковолосистый; распростертые, как бы обволакивающие субстрат — флебия гигантская. У некоторых трутовиков основание плодового тела вытягивается в более или менее длинную ножку, например у лакированного трутовика. Размеры плодовых тел у трутовиков, как и у шляпочных грибов, колеблются в широких пределах — от гигантских, размером до 0,5-1 м (плоский трутовик, настоящий трутовик и некоторые другие), до крошечных, не превышающих в диаметре 0,5-1 см.
На древесине и почве в лесу можно видеть и макромицеты необычной формы, внешне иногда совершенно непохожие на грибы. Например, гриб-баран, или разветвленный трутовик, выглядит как большой букет из многочисленных (до 200 и более) шляпочных грибов, расположенных на сильно разветвленной ножке, а гериций, или ежевик коралловидный, получил свое название за сходство его обильно разветвленного, покрытого многочисленными шипиками белого с кремовым или розоватым оттенком плодового тела с кораллом. В лесу часто встречаются и многочисленные рогатики, плодовые телакоторых имеют булавовидную форму или выглядят как обильно разветвленные кустики.
Большим многообразием отличаются плодовые тела гастеромицетов, или нутревиков, получивших такое название потому, что споры у них образуются внутри плодового тела, одетого до их созревания плотной оболочкой. Среди них широко распространенные в наших лесах дождевики с шаровидными или грушевидными плодовыми телами, покрытыми часто шипиками или чешуйками, и лангермания гигантская — один из наиболее крупных грибов, плодовое тело которого может достигать диаметра 70-100 см и массы более 12 кг. У веселки обыкновенной и диктиофоры сдвоенной плодовые тела имеют вид складчатой темно-зеленой или оливковой слизистой шляпки, высоко поднятой на белой губчатой ножке — рецептакуле, а у последней из них от основания шляпки на ножку спускается еще длинная сетчатая ажурная "юбочка", за что этот гриб иногда называют "дама с вуалью". Плодовые тела гнездовок вообще не похожи на грибы, а скорее напоминают крошечные, диаметром около 1 см, птичьи гнезда с яйцами. Особенно разнообразны тропические и субтропические гастеромицеты, получившие еще в прошлом веке название "грибы-цветы" за необычайное разнообразие форм и яркость окраски. Это решеточники, цветохвостники и многие другие. В нашей стране некоторые из них встречаются в Закавказье, а иногда с почвой или посадочным материалом попадают в оранжереи и ботанические сады разных районов.
 'Дама с вуалью', или диктиофора сдвоенная
Всем известны сморчки и строчки с их складчатыми шляпками на ножках. На почве, гниющей древесине и поверхности кострищ в лесах часто можно встретить их ближайших родственников — пецицы, алеврии и др. Их плодовые тела совсем не похожи на сморчки, они обычно довольно мелкие и имеют вид дисков, чашек или бокальчиков желтоватого, коричневого, а иногда и ярких цветов — оранжевого или красного. За форму плодовых тел они получили общее название дискомицеты (диском часто называют несущую споры часть их плодового тела). Некоторые из дискомицетов, встречающихся у нас в лесах средней полосы, по яркости и красоте не уступают даже тропическим гастеромицетам. Встречающаяся ранней весной микростома вытянутая, например, образует небольшие бокаловидные плодовые тела с ярко-красным диском; в зрелом возрасте они разрываются на лопасти и выглядят как яркие огненные цветы.
'Дама с вуалью', или диктиофора сдвоенная
Всем известны сморчки и строчки с их складчатыми шляпками на ножках. На почве, гниющей древесине и поверхности кострищ в лесах часто можно встретить их ближайших родственников — пецицы, алеврии и др. Их плодовые тела совсем не похожи на сморчки, они обычно довольно мелкие и имеют вид дисков, чашек или бокальчиков желтоватого, коричневого, а иногда и ярких цветов — оранжевого или красного. За форму плодовых тел они получили общее название дискомицеты (диском часто называют несущую споры часть их плодового тела). Некоторые из дискомицетов, встречающихся у нас в лесах средней полосы, по яркости и красоте не уступают даже тропическим гастеромицетам. Встречающаяся ранней весной микростома вытянутая, например, образует небольшие бокаловидные плодовые тела с ярко-красным диском; в зрелом возрасте они разрываются на лопасти и выглядят как яркие огненные цветы.
 Многообразие видов грибовМногообразие видов грибов
Многообразие видов грибовМногообразие видов грибов
 Плодовое тело грибов
Плодовое тело грибов
 Многообразие видов грибов
Многообразие видов грибов
 Плодовое тело грибов
Плодовое тело грибов
 Все многообразие грибов — это прежде всего многообразие плодовых тел, на которых образуются споры, служащие для размножения
Все многообразие грибов — это многообразие прежде всего тех их структур (плодовых тел и др.), на которых образуются споры, служащие для размножения. В процессе эволюции грибов именно они претерпели наибольшие изменения, связанные с увеличением количества образуемых спор и совершенствованием способов их распространения. Что же касается вегетативного тела гриба, выполняющего функции питания, распространения по субстрату, дыхания, то у большинства грибов это мицелий (или грибница), состоящий из многочисленных тонких ветвящихся нитей — гиф. По внешнему виду мицелий часто сходен даже у далеких по происхождению грибов, в отличие от разнообразных органов спороношения, образующихся на нем. Его гифы обычно очень тонкие и не превышают по толщине 5-6, реже — 10 мкм. Окраска их от белой, желтоватой до темной — оливковой, бурой или черной. Иногда встречаются грибы с яркоокрашенным мицелием — розовым, желтым, красным. Таким образом, довольно распространенное деление грибов на макромицеты и микромицеты условно, так как вегетативное тело у тех и других — это микроскопический мицелий.
Все многообразие грибов — это прежде всего многообразие плодовых тел, на которых образуются споры, служащие для размножения
Все многообразие грибов — это многообразие прежде всего тех их структур (плодовых тел и др.), на которых образуются споры, служащие для размножения. В процессе эволюции грибов именно они претерпели наибольшие изменения, связанные с увеличением количества образуемых спор и совершенствованием способов их распространения. Что же касается вегетативного тела гриба, выполняющего функции питания, распространения по субстрату, дыхания, то у большинства грибов это мицелий (или грибница), состоящий из многочисленных тонких ветвящихся нитей — гиф. По внешнему виду мицелий часто сходен даже у далеких по происхождению грибов, в отличие от разнообразных органов спороношения, образующихся на нем. Его гифы обычно очень тонкие и не превышают по толщине 5-6, реже — 10 мкм. Окраска их от белой, желтоватой до темной — оливковой, бурой или черной. Иногда встречаются грибы с яркоокрашенным мицелием — розовым, желтым, красным. Таким образом, довольно распространенное деление грибов на макромицеты и микромицеты условно, так как вегетативное тело у тех и других — это микроскопический мицелий.
Строение грибов
Мицелий грибов значительно труднее обнаружить в природе, чем их спороношения и особенно плодовые тела, потому что он обычно большей своей частью или весь погружен в субстрат (так называемый субстратный мицелий). Он пронизывает почву, подстилку, древесину или проникает в ткани растения-хозяина и т. п., где всей своей поверхностью или при помощи специальных структур (у многих паразитов) поглощает питательные вещества. Споры же, за немногим исключением, образуются на поверхности субстрата — на воздушном мицелии или специальных структурах, например плодовых телах, что необходимо для эффективного распространения. Неудивительно поэтому, что споры грибов и их роль в размножении были открыты значительно раньше, чем их вегетативное тело — мицелий. Схема проростания споры и радиального роста грибницы
Мицелий грибов обычно развивается из споры, реже — из кусочков мицелия или других вегетативных структур. Прорастая, спора образует ростковую трубку, которая вначале удлиняется, а затем начинает ветвиться. Рост у мицелия всегда верхушечный, а ветвление боковое, разрастается он радиально по всем направлениям. Это хорошо видно при наблюдении за развитием культуры грибов на твердых питательных средах в чашках Петри, где колонии грибов имеют, как правило, более или менее правильную круглую форму.
Схема проростания споры и радиального роста грибницы
Мицелий грибов обычно развивается из споры, реже — из кусочков мицелия или других вегетативных структур. Прорастая, спора образует ростковую трубку, которая вначале удлиняется, а затем начинает ветвиться. Рост у мицелия всегда верхушечный, а ветвление боковое, разрастается он радиально по всем направлениям. Это хорошо видно при наблюдении за развитием культуры грибов на твердых питательных средах в чашках Петри, где колонии грибов имеют, как правило, более или менее правильную круглую форму.
 Грибница микроскопических грибов тоже растет по кругу
Скорость роста мицелия у разных грибов различна и в значительной степени зависит от условий внешней среды. В культуре на твердых питательных средах скорость роста мицелия у многих грибов достигает 2-3 см в день (например, у мукора, триходермы), другие растут в этих условиях более медленно, образуя через 10-14 дней роста колонии диаметром всего 1-2 см. В природных условиях рост мицелия обычно более медленный, чем в культуре: у шляпочных грибов, например, составляет 10-20, реже до 30-50 см в год.
Продолжительность жизни мицелия у разных грибов также различна: у одних он недолговечен и после образования спор отмирает, а у других может существовать много лет. У трутовиков мицелий может жить в дереве в течение нескольких лет. Такие грибы часто начинают развиваться в живом дереве, а когда это дерево погибнет, продолжают расти на погибшем. Многолетний мицелий и у многих наших обычных шляпочных грибов. Его возраст может достигать 10-25 лет, хотя в некоторых местах были обнаружены грибницы возраста до 500 лет и более.
Грибница микроскопических грибов тоже растет по кругу
Скорость роста мицелия у разных грибов различна и в значительной степени зависит от условий внешней среды. В культуре на твердых питательных средах скорость роста мицелия у многих грибов достигает 2-3 см в день (например, у мукора, триходермы), другие растут в этих условиях более медленно, образуя через 10-14 дней роста колонии диаметром всего 1-2 см. В природных условиях рост мицелия обычно более медленный, чем в культуре: у шляпочных грибов, например, составляет 10-20, реже до 30-50 см в год.
Продолжительность жизни мицелия у разных грибов также различна: у одних он недолговечен и после образования спор отмирает, а у других может существовать много лет. У трутовиков мицелий может жить в дереве в течение нескольких лет. Такие грибы часто начинают развиваться в живом дереве, а когда это дерево погибнет, продолжают расти на погибшем. Многолетний мицелий и у многих наших обычных шляпочных грибов. Его возраст может достигать 10-25 лет, хотя в некоторых местах были обнаружены грибницы возраста до 500 лет и более.
 'Ведьмино кольцо', образованное лисичками
Радиальный рост мицелия наблюдается не только в культуре на питательных средах, но и в естественных условиях, например в почве. С таким характером его роста связано интересное явление, получившее название "ведьмины кольца" или "ведьмины круги". Плодовые тела многих макромицетов, например лугового опенка, некоторых шампиньонов, говорушек, фиолетовой рядовки, кудонии и др., образуются не поодиночке или небольшими группами, а образуют хорошо заметные кольца разного диаметра, обычно от 3-5 до 20-50 м, реже большего. Кольца правильной формы и большого размера чаще можно наблюдать на открытых пространствах — лугах, в степях, а в лесах в основном на полянах — здесь кольца часто прерывисты. При благоприятных условиях и на открытых пространствах кольца могут существовать много лет, достигая иногда огромных размеров. В 1917 г. в прериях штата Колорадо (США) наблюдали "ведьмины кольца" не менее 400-летнего возраста и фрагменты кольца возраста не менее 650 лет, причем диаметр этих колец был около 200 м. В заповедных целинных степях Украины и в наши дни встречаются кольца шампиньона таблитчатого, диаметр которых достигает иногда 80 м.
'Ведьмино кольцо', образованное лисичками
Радиальный рост мицелия наблюдается не только в культуре на питательных средах, но и в естественных условиях, например в почве. С таким характером его роста связано интересное явление, получившее название "ведьмины кольца" или "ведьмины круги". Плодовые тела многих макромицетов, например лугового опенка, некоторых шампиньонов, говорушек, фиолетовой рядовки, кудонии и др., образуются не поодиночке или небольшими группами, а образуют хорошо заметные кольца разного диаметра, обычно от 3-5 до 20-50 м, реже большего. Кольца правильной формы и большого размера чаще можно наблюдать на открытых пространствах — лугах, в степях, а в лесах в основном на полянах — здесь кольца часто прерывисты. При благоприятных условиях и на открытых пространствах кольца могут существовать много лет, достигая иногда огромных размеров. В 1917 г. в прериях штата Колорадо (США) наблюдали "ведьмины кольца" не менее 400-летнего возраста и фрагменты кольца возраста не менее 650 лет, причем диаметр этих колец был около 200 м. В заповедных целинных степях Украины и в наши дни встречаются кольца шампиньона таблитчатого, диаметр которых достигает иногда 80 м.
 Еще одно 'ведьмино кольцо': коллибии на старом грибе
Люди давно обратили внимание на такие кольца. Заметили они и разный характер роста травы в разных зонах кольца. Внутри его, в центральной части, и за его пределами в непосредственной близости от плодовых тел гриба трава развивается буйно и имеет интенсивно зеленую окраску, а между этими зонами рост травы сильно подавлен и даже наблюдается ее гибель. В научной литературе такие кольца, образуемые луговым опенком, впервые были описаны в 1718 г. Однако в то время еще неизвестна была грибница шляпочных грибов, и тайну "ведьминых колец" удалось разгадать значительно позднее, уже в начале нашего века.
Как же образуются "ведьмины кольца" и почему трава в разных зонах выглядит по-разному? На поперечном разрезе "ведьмина кольца" видно, что мицелий в кольце нарастает радиально и молодая, наиболее активная его часть располагается по его периферии. Здесь и происходит образование плодовых тел. В том месте круга, где наиболее интенсивен рост мицелия, он густо пронизывает почву, образуя часто плотные сплетения, затрудняющие нормальный доступ воды к корням растения. В этой зоне наблюдается так называемая физиологическая засуха, которая и вызывает гибель растений. Кроме того, химический анализ почвы в такой зоне обнаруживает высокую концентрацию соединений азота, гибельную для растений. В центре же старых кругов мицелий отмирает, почва обогащается продуктами ею распада и минерализации, стимулирующими рост растений. Стимуляция роста наблюдается и в зоне нарастания молодого мицелия, за пределами кольца плодовых тел. С помощью гидролитических ферментов мицелий гриба разлагает белки и другие органические соединения, находящиеся в почве, а почвенные бактерии превращают образующийся аммиак в нитраты, которые и используются растениями.
Внешне мицелий разных грибов сходен, однако по строению существенно отличается у разных их групп. У более примитивных грибов он неклеточный (ценоцитный). Такой мицелий представляет собой как бы одну гигантскую клетку с огромным числом ядер. Иногда в нем образуются перегородки, отделяющие поврежденные его участки и органы размножения. Ценоцитный мицелий известен у многих водных (сапролегнии и др.) и наземных грибов (мукора, ризопуса и др.).
У более высокоорганизованных грибов, которые часто называют высшими, мицелий имеет характерное строение — разделен перегородками на отдельные клетки, содержащие от одного до нескольких (их может быть много) ядер. Перегородка (септа) у этих грибов развивается от стенки гифы к ее центру (центрипетально), напоминая закрывающуюся ирисовую диафрагму у фотоаппарата, а в центре ее всегда остается отверстие — пора. Это очень важно для функционирования мицелия, так как поры обеспечивают перемещение в клеточном мицелии веществ и даже клеточных органелл.
У некоторых грибов, например дрожжей, мицелий отсутствует, а их вегетативное тело представлено одиночными почкующимися или делящимися клетками. Образование дрожжеподобной фазы наблюдается иногда и у мицелиальных грибов, поэтому предполагают, что такой тип вегетативного тела у грибов — это адаптация к обитанию в определенных условиях, например в сахаристых жидкостях: истечениях, деревьев, соке плодов и т. д.
В процессе эволюции грибов мицелий появился не сразу. У наиболее примитивных из ныне живущих грибов сохранилось вегетативное тело в виде голого протопласта, лишенного собственной клеточной стенки и развивающегося внутри клетки хозяина. Вероятно, в далеком прошлом, на заре происхождения грибов организмы с таким вегетативным телом были и свободноживущими, однако сейчас оно сохранилось только у внутриклеточных паразитов. Некоторые микологи считают его вторично упрощенным в связи с внутриклеточным паразитизмом. Такое вегетативное тело обычно недолговечно, через несколько дней оно превращается в зооспорангий с подвижными спорами, которые снова заражают подходящего хозяина.
В эволюционном отношении одноклеточное вегетативное тело у грибов — осмотрофных организмов — оказалось малоперспективным. Его рост не может происходить неограниченно, так как по мере увеличения размеров клетки ее объем возрастает значительно быстрее, чем поверхность, а это затрудняет обмен веществ с окружающей средой. Кроме того, развитие одноклеточных организмов ограничено небольшим пространством, обычно одной клеткой хозяина, поэтому их существование кратковременно и завершается после исчерпания питания, которое может дать одна клетка. Поэтому в процессе эволюции грибов увеличение размеров их вехетативного тела пошло по пути образования нитчатых — мицелиальных форм. В этом случае поверхность тела и его объем увеличиваются параллельно и становится возможным практически неограниченный рост и наиболее эффективное использование субстрата организмом. Образование нитчатых форм имеет, таким образом, большие преимущества и наблюдается не только у грибов, но и у других групп организмов — водорослей и актиномицетов.
Хорошо развитый мицелий появляется у грибов, уже достаточно высокоразвитых.
А первичный мицелий, существующий и у некоторых современных грибов, это, вероятно, зачаточный мицелий, или ризомицелий, он лишен собственных ядер и не может развиваться самостоятельно и регенерировать, как настоящий. Однако он уже обеспечивает, пусть еще очень примитивную, дифференциацию вегетативного тела и возможность существования части ею вне питающего субстрата: в субстрат проникает только ризомицелий, который выполняет некоторые функции мицелия — прикрепление к субстрату, поглощение питательных веществ и транспортировку их в основную часть тела.
Преимущества мицелия несомненны: он способен распространяться на большие расстояния и захватывать большие участки субстрата, особенно у грибов с большой скоростью роста или с многолетним мицелием. Имея максимально возможную поверхность по отношению к объему, он представляет оптимальную структуру для осмотрофных организмов. Мицелий, кроме того, дает большие возможности для дифференциации тела грибов, что особенно важно в наземных условиях существования, где они подвергаются многочисленным неблагоприятным воздействиям внешней среды — сильной инсоляции, влиянию сухого воздуха и т. п. Очень часто мы встречаем дифференциацию мицелия на две функционально различные части: субстратный мицелий, служащий для прикрепления к субстрату, его заселения, поглощения и транспортировки питательных веществ и воды, и воздушный мицелий, поднимающийся над субстратом и образующий органы размножения. Наконец, мицелий дает грибам необыкновенно широкие морфогенетические (формообразовательные) возможности. На его основе у грибов возникают многочисленные приспособления, связанные с условиями их обитания и образом жизни. Это и образование различных видоизменений мицелия, и таких сложных структур, как плодовые тела, нередко, как мы уже видели, достигающих крупных размеров и сложного строения. Все эти структуры образуются у грибов только из мицелия, так как настоящие ткани, образующиеся в результате деления клеток в трех взаимно перпендикулярных направлениях, встречаются у грибов крайне редко, а их функции выполняют так называемые ложные ткани, или плектенхимы, представляющие собой переплетения гиф.
Еще одно 'ведьмино кольцо': коллибии на старом грибе
Люди давно обратили внимание на такие кольца. Заметили они и разный характер роста травы в разных зонах кольца. Внутри его, в центральной части, и за его пределами в непосредственной близости от плодовых тел гриба трава развивается буйно и имеет интенсивно зеленую окраску, а между этими зонами рост травы сильно подавлен и даже наблюдается ее гибель. В научной литературе такие кольца, образуемые луговым опенком, впервые были описаны в 1718 г. Однако в то время еще неизвестна была грибница шляпочных грибов, и тайну "ведьминых колец" удалось разгадать значительно позднее, уже в начале нашего века.
Как же образуются "ведьмины кольца" и почему трава в разных зонах выглядит по-разному? На поперечном разрезе "ведьмина кольца" видно, что мицелий в кольце нарастает радиально и молодая, наиболее активная его часть располагается по его периферии. Здесь и происходит образование плодовых тел. В том месте круга, где наиболее интенсивен рост мицелия, он густо пронизывает почву, образуя часто плотные сплетения, затрудняющие нормальный доступ воды к корням растения. В этой зоне наблюдается так называемая физиологическая засуха, которая и вызывает гибель растений. Кроме того, химический анализ почвы в такой зоне обнаруживает высокую концентрацию соединений азота, гибельную для растений. В центре же старых кругов мицелий отмирает, почва обогащается продуктами ею распада и минерализации, стимулирующими рост растений. Стимуляция роста наблюдается и в зоне нарастания молодого мицелия, за пределами кольца плодовых тел. С помощью гидролитических ферментов мицелий гриба разлагает белки и другие органические соединения, находящиеся в почве, а почвенные бактерии превращают образующийся аммиак в нитраты, которые и используются растениями.
Внешне мицелий разных грибов сходен, однако по строению существенно отличается у разных их групп. У более примитивных грибов он неклеточный (ценоцитный). Такой мицелий представляет собой как бы одну гигантскую клетку с огромным числом ядер. Иногда в нем образуются перегородки, отделяющие поврежденные его участки и органы размножения. Ценоцитный мицелий известен у многих водных (сапролегнии и др.) и наземных грибов (мукора, ризопуса и др.).
У более высокоорганизованных грибов, которые часто называют высшими, мицелий имеет характерное строение — разделен перегородками на отдельные клетки, содержащие от одного до нескольких (их может быть много) ядер. Перегородка (септа) у этих грибов развивается от стенки гифы к ее центру (центрипетально), напоминая закрывающуюся ирисовую диафрагму у фотоаппарата, а в центре ее всегда остается отверстие — пора. Это очень важно для функционирования мицелия, так как поры обеспечивают перемещение в клеточном мицелии веществ и даже клеточных органелл.
У некоторых грибов, например дрожжей, мицелий отсутствует, а их вегетативное тело представлено одиночными почкующимися или делящимися клетками. Образование дрожжеподобной фазы наблюдается иногда и у мицелиальных грибов, поэтому предполагают, что такой тип вегетативного тела у грибов — это адаптация к обитанию в определенных условиях, например в сахаристых жидкостях: истечениях, деревьев, соке плодов и т. д.
В процессе эволюции грибов мицелий появился не сразу. У наиболее примитивных из ныне живущих грибов сохранилось вегетативное тело в виде голого протопласта, лишенного собственной клеточной стенки и развивающегося внутри клетки хозяина. Вероятно, в далеком прошлом, на заре происхождения грибов организмы с таким вегетативным телом были и свободноживущими, однако сейчас оно сохранилось только у внутриклеточных паразитов. Некоторые микологи считают его вторично упрощенным в связи с внутриклеточным паразитизмом. Такое вегетативное тело обычно недолговечно, через несколько дней оно превращается в зооспорангий с подвижными спорами, которые снова заражают подходящего хозяина.
В эволюционном отношении одноклеточное вегетативное тело у грибов — осмотрофных организмов — оказалось малоперспективным. Его рост не может происходить неограниченно, так как по мере увеличения размеров клетки ее объем возрастает значительно быстрее, чем поверхность, а это затрудняет обмен веществ с окружающей средой. Кроме того, развитие одноклеточных организмов ограничено небольшим пространством, обычно одной клеткой хозяина, поэтому их существование кратковременно и завершается после исчерпания питания, которое может дать одна клетка. Поэтому в процессе эволюции грибов увеличение размеров их вехетативного тела пошло по пути образования нитчатых — мицелиальных форм. В этом случае поверхность тела и его объем увеличиваются параллельно и становится возможным практически неограниченный рост и наиболее эффективное использование субстрата организмом. Образование нитчатых форм имеет, таким образом, большие преимущества и наблюдается не только у грибов, но и у других групп организмов — водорослей и актиномицетов.
Хорошо развитый мицелий появляется у грибов, уже достаточно высокоразвитых.
А первичный мицелий, существующий и у некоторых современных грибов, это, вероятно, зачаточный мицелий, или ризомицелий, он лишен собственных ядер и не может развиваться самостоятельно и регенерировать, как настоящий. Однако он уже обеспечивает, пусть еще очень примитивную, дифференциацию вегетативного тела и возможность существования части ею вне питающего субстрата: в субстрат проникает только ризомицелий, который выполняет некоторые функции мицелия — прикрепление к субстрату, поглощение питательных веществ и транспортировку их в основную часть тела.
Преимущества мицелия несомненны: он способен распространяться на большие расстояния и захватывать большие участки субстрата, особенно у грибов с большой скоростью роста или с многолетним мицелием. Имея максимально возможную поверхность по отношению к объему, он представляет оптимальную структуру для осмотрофных организмов. Мицелий, кроме того, дает большие возможности для дифференциации тела грибов, что особенно важно в наземных условиях существования, где они подвергаются многочисленным неблагоприятным воздействиям внешней среды — сильной инсоляции, влиянию сухого воздуха и т. п. Очень часто мы встречаем дифференциацию мицелия на две функционально различные части: субстратный мицелий, служащий для прикрепления к субстрату, его заселения, поглощения и транспортировки питательных веществ и воды, и воздушный мицелий, поднимающийся над субстратом и образующий органы размножения. Наконец, мицелий дает грибам необыкновенно широкие морфогенетические (формообразовательные) возможности. На его основе у грибов возникают многочисленные приспособления, связанные с условиями их обитания и образом жизни. Это и образование различных видоизменений мицелия, и таких сложных структур, как плодовые тела, нередко, как мы уже видели, достигающих крупных размеров и сложного строения. Все эти структуры образуются у грибов только из мицелия, так как настоящие ткани, образующиеся в результате деления клеток в трех взаимно перпендикулярных направлениях, встречаются у грибов крайне редко, а их функции выполняют так называемые ложные ткани, или плектенхимы, представляющие собой переплетения гиф.
 Типы мицелия у различных грибов: 1 — ризомицелий; 2 , 3 — соответственно неклеточный и клеточный мицелий; 4 — дрожжи — разновидность мицелия
Примером настоящих тканей у грибов может служить вегетативное тело (рецептакул) у весьма своеобразной группы грибов — лябульбениевых, высокоспециализированных паразитов насекомых. Под бинокулярной лупой рецептакул этих грибов имеет вид темноокрашенных щетинок или волосков, расположенных на поверхности покровов насекомого. Эта группа грибов так отличается от всех остальных, что долгое время ее относили не к ним, а считали патологическими структурами на теле насекомых или неизвестными растительными паразитами.
Видоизменения мицелия, которые чаще всего встречаются у макромицетов, — мицелиальные тяжи и ризоморфы. Функции их — распространение гриба и транспортировка питательных веществ и воды. Мицелиальные тяжи представляют собой пучки гиф, имеющие толщину от долей миллиметра до нескольких миллиметров. Как и одиночные гифы, мицелиальные тяжи пронизывают субстрат и могут достигать в длину нескольких метров. Они образуются у многих шляпочных грибов, трутовиков, гастеромицетов, дискомицетов и др. и хорошо видны как беловатые или окрашенные нити у основания сорванных плодовых тел.
У настоящего домового гриба, кроме мицелиальных тяжей, образуются также ватообразные скопления мицелия и мицелиальные пленки. Они очень быстро распространяются по деревянным конструкциям зданий, а также могут преодолевать препятствия, например участки каменных стен.
Типы мицелия у различных грибов: 1 — ризомицелий; 2 , 3 — соответственно неклеточный и клеточный мицелий; 4 — дрожжи — разновидность мицелия
Примером настоящих тканей у грибов может служить вегетативное тело (рецептакул) у весьма своеобразной группы грибов — лябульбениевых, высокоспециализированных паразитов насекомых. Под бинокулярной лупой рецептакул этих грибов имеет вид темноокрашенных щетинок или волосков, расположенных на поверхности покровов насекомого. Эта группа грибов так отличается от всех остальных, что долгое время ее относили не к ним, а считали патологическими структурами на теле насекомых или неизвестными растительными паразитами.
Видоизменения мицелия, которые чаще всего встречаются у макромицетов, — мицелиальные тяжи и ризоморфы. Функции их — распространение гриба и транспортировка питательных веществ и воды. Мицелиальные тяжи представляют собой пучки гиф, имеющие толщину от долей миллиметра до нескольких миллиметров. Как и одиночные гифы, мицелиальные тяжи пронизывают субстрат и могут достигать в длину нескольких метров. Они образуются у многих шляпочных грибов, трутовиков, гастеромицетов, дискомицетов и др. и хорошо видны как беловатые или окрашенные нити у основания сорванных плодовых тел.
У настоящего домового гриба, кроме мицелиальных тяжей, образуются также ватообразные скопления мицелия и мицелиальные пленки. Они очень быстро распространяются по деревянным конструкциям зданий, а также могут преодолевать препятствия, например участки каменных стен.
 Ризоморфы опенка осеннего
Хорошо развитые и дифференцированные мицелиальные тяжи получили название ризоморф. Ризоморфы — большей частью темноокрашенные шнуры. Гифы их наружных слоев имеют утолщенные темноокрашенные стенки и выполняют защитные функции, а внутренние проводящие гифы — тонкостенные и светлоокрашенные. Хорошо развитые ризоморфы, длиной до нескольких метров, образуют широко распространенный осенний опенок — опасный паразит деревьев и кустарников, способный заражать около 200 видов растений. При помощи ризоморф этот гриб легко перемещается от дерева к дереву и вызывает их заражение. Именно благодаря ризоморфам он нередко способен образовывать плодовые тела на сухих стволах деревьев, особенно берез, на высоте 2-3 м, а иногда и более над землей.
Другой тип видоизменений мицелия — склероции. Это плотные переплетения мицелия, служащие для перенесения неблагоприятных условий. Клетки склероциев богаты запасными питательными веществами — гликогеном, жирами; в склероциях спорыньи, например, жиры составляют до 30% содержимого клеток. Часто склероции дифференцированы на кору — наружный слой клеток, обычно толстостенных и темноокрашенных, и внутреннюю часть из тонкостенных светлоокрашенных клеток.
Склероции образуют очень многие грибы, у некоторых они представляют зимующие стадии, например у спорыньи, ботритиса серого, вызывающего серую плесень у многих растений, и др. Они известны и у некоторых макромицетов. У коллибии Кука, развивающейся на гниющих остатках шляпочных грибов, плодовые тела образуются из маленьких зерновидных склероциев охряного или красновато-рыжего цвета. Из черного небольшого склероция развиваются и плодовые тела уже упоминавшейся микростомы вытянутой, а у одного из тропических полипорусов склероции достигают огромных размеров (масса их до 20 кг) и съедобны .
На мицелии многих микроскопических грибов образуются специализированные структуры, связанные с их способом питания. Так, у паразитов, питающихся за счет живых тканей растений или других организмов, часто имеются гаустории — специальные веточки мицелия, проникающие в клетки хозяина и поглощающие из них питательные вещества. Гаустории известны у самых разных групп грибов-паразитов — у ложномучнисторосяных, мучнисторосяных и у ржавчинных, паразитирующих на растениях, у некоторых мукоровых, паразитирующих на грибах, и у многих других. На гаустории похожи и арбускулы некоторых микоризных грибов.
Ризоморфы опенка осеннего
Хорошо развитые и дифференцированные мицелиальные тяжи получили название ризоморф. Ризоморфы — большей частью темноокрашенные шнуры. Гифы их наружных слоев имеют утолщенные темноокрашенные стенки и выполняют защитные функции, а внутренние проводящие гифы — тонкостенные и светлоокрашенные. Хорошо развитые ризоморфы, длиной до нескольких метров, образуют широко распространенный осенний опенок — опасный паразит деревьев и кустарников, способный заражать около 200 видов растений. При помощи ризоморф этот гриб легко перемещается от дерева к дереву и вызывает их заражение. Именно благодаря ризоморфам он нередко способен образовывать плодовые тела на сухих стволах деревьев, особенно берез, на высоте 2-3 м, а иногда и более над землей.
Другой тип видоизменений мицелия — склероции. Это плотные переплетения мицелия, служащие для перенесения неблагоприятных условий. Клетки склероциев богаты запасными питательными веществами — гликогеном, жирами; в склероциях спорыньи, например, жиры составляют до 30% содержимого клеток. Часто склероции дифференцированы на кору — наружный слой клеток, обычно толстостенных и темноокрашенных, и внутреннюю часть из тонкостенных светлоокрашенных клеток.
Склероции образуют очень многие грибы, у некоторых они представляют зимующие стадии, например у спорыньи, ботритиса серого, вызывающего серую плесень у многих растений, и др. Они известны и у некоторых макромицетов. У коллибии Кука, развивающейся на гниющих остатках шляпочных грибов, плодовые тела образуются из маленьких зерновидных склероциев охряного или красновато-рыжего цвета. Из черного небольшого склероция развиваются и плодовые тела уже упоминавшейся микростомы вытянутой, а у одного из тропических полипорусов склероции достигают огромных размеров (масса их до 20 кг) и съедобны .
На мицелии многих микроскопических грибов образуются специализированные структуры, связанные с их способом питания. Так, у паразитов, питающихся за счет живых тканей растений или других организмов, часто имеются гаустории — специальные веточки мицелия, проникающие в клетки хозяина и поглощающие из них питательные вещества. Гаустории известны у самых разных групп грибов-паразитов — у ложномучнисторосяных, мучнисторосяных и у ржавчинных, паразитирующих на растениях, у некоторых мукоровых, паразитирующих на грибах, и у многих других. На гаустории похожи и арбускулы некоторых микоризных грибов.
 Наиболее извесный тип ловушек хищных грибов — сжимающиеся кольца на ножке, состоящие из трех клеток; в ответ на прикосновение нематоды клетки кольца резко увеличиваются в объеме и захваченная кольцом нематода погибает от сдавливания
Очень интересны структуры ловчих приспособлений хищных грибов, которые питаются совершенно необычным способом: ловят, убивают и используют в пищу микроскопически мелких животных — нематод, коловраток, простейших и др. Эти грибы в больших количествах присутствуют везде, где есть их жертвы — в почве, гниющей древесине, дернинках мхов и т. д. Жертву хищные грибы захватывают при помощи различных ловушек, чаще всего клейких сетей, состоящих из большого числа колец. Такие сети образуются в результате обильного ветвления гиф, веточки которых загибаются и соединяются (анастомозируют) с соседними веточками или родительской гифой, образуя сложную трехмерную сеть. Поверхность сети покрыта клейким веществом, близким, по-видимому, к смолам и гутте. Прикоснувшись к сети, нематода прилипает к ней, а пытаясь освободиться, активно движется, извивается и еще больше прилипает. Через некоторое время она перестает двигаться, а из сети развивается гифа, проникающая в ее тело, и разрастается там.
Содержимое тела нематоды используется хищным грибом очень быстро — в течение суток. Интересно отметить, что ловушки образуются на мицелии обычно в присутствии нематод. У некоторых нематод обнаружено образование веществ, индуцирующих формирование ловушек. Некоторые хищные грибы образуют ловушки и в отсутствии нематод, в условиях относительного голодания и недостатка воды.
Мы рассмотрели только некоторые типы приспособительных видоизменений мицелия у грибов. Важно отметить, что сходные приспособления наблюдаются у грибов, далеких по происхождению, но обитающих в сходных условиях внешней среды. Такое явление сходства структур или функций у неблизкородственных организмов при адаптации их к сходным условиям обитания получило название конвергенции.
Наиболее извесный тип ловушек хищных грибов — сжимающиеся кольца на ножке, состоящие из трех клеток; в ответ на прикосновение нематоды клетки кольца резко увеличиваются в объеме и захваченная кольцом нематода погибает от сдавливания
Очень интересны структуры ловчих приспособлений хищных грибов, которые питаются совершенно необычным способом: ловят, убивают и используют в пищу микроскопически мелких животных — нематод, коловраток, простейших и др. Эти грибы в больших количествах присутствуют везде, где есть их жертвы — в почве, гниющей древесине, дернинках мхов и т. д. Жертву хищные грибы захватывают при помощи различных ловушек, чаще всего клейких сетей, состоящих из большого числа колец. Такие сети образуются в результате обильного ветвления гиф, веточки которых загибаются и соединяются (анастомозируют) с соседними веточками или родительской гифой, образуя сложную трехмерную сеть. Поверхность сети покрыта клейким веществом, близким, по-видимому, к смолам и гутте. Прикоснувшись к сети, нематода прилипает к ней, а пытаясь освободиться, активно движется, извивается и еще больше прилипает. Через некоторое время она перестает двигаться, а из сети развивается гифа, проникающая в ее тело, и разрастается там.
Содержимое тела нематоды используется хищным грибом очень быстро — в течение суток. Интересно отметить, что ловушки образуются на мицелии обычно в присутствии нематод. У некоторых нематод обнаружено образование веществ, индуцирующих формирование ловушек. Некоторые хищные грибы образуют ловушки и в отсутствии нематод, в условиях относительного голодания и недостатка воды.
Мы рассмотрели только некоторые типы приспособительных видоизменений мицелия у грибов. Важно отметить, что сходные приспособления наблюдаются у грибов, далеких по происхождению, но обитающих в сходных условиях внешней среды. Такое явление сходства структур или функций у неблизкородственных организмов при адаптации их к сходным условиям обитания получило название конвергенции.
Размножение грибов
Размножение грибов происходит при помощи спор, а также кусочков мицелия, склероциев и других структур. Любой элемент, который может дать начало новому мицелию, часто называют диаспорой или пропагулой. По происхождению диаспоры могут быть специализированными, т. е. образующимися специально для размножения (споры), или неспециализированными (например, фрагменты мицелия). Размножение неспециализированными диаспорами получило название вегетативного, так как оно происходит за счет участков или структур вегетативного тела грибов. Мицелиальные грибы чаще размножаются кусочками мицелия. Этот способ обычно используют для размножения многих грибов, например шампиньонов, вешенки, летнего опенка и др., в культуре. Споры грибов служат для размножения. Они состоят из одной или нескольких клеток и имеют микроскопические размеры — от 1-2 до 100 мк и более. За относительно немногими исключениями, споры содержат мало запасных питательных веществ, только немногие выживают и, попав в подходящие условия, прорастают, давая начало новому мицелию. Однако гибель компенсируется образованием огромного количества спор. Так, возбудитель стеблевой ржавчины злаков образует весной и в начале лета на одном кусте барбариса до 64 • 1012 спор, плодовое тело трутовика средних размеров до 25-30 млрд., а шампиньоны около 40 млн. спор в час. По происхождению и роли в жизни грибов споры делятся на две большие группы: споры бесполого размножения, или митоспоры, и споры полового размножения, или мейоспоры. Образованию митоспор предшествует митотическое деление клеточного ядра, т. е. деление, не сопровождающееся сокращением числа хромосом. В противоположность этому образованию мейоспор предшествует мейоз — деление ядра клетки, сопровождающееся сокращением числа хромосом вдвое. Митоспоры и мейоспоры различаются не только происхождением, но функциями. Митоспоры служат преимущественно для массового расселения грибов в период вегетации, без рекомбинации наследственных признаков. При бесполом размножении в принципе происходит образование точных копий, идентичных родителям, а изменчивость возникает в основном за счет мутаций — наследственных изменений в генах. Однако в природе мы встречаемся обычно с большой изменчивостью грибов, размножающихся митоспорами. Это связано с образованием огромных их количеств, при которых даже при низкой частоте мутаций те из них, которые благоприятны для жизни гриба в существующих условиях, сохраняются и накапливаются, создавая большое разнообразие в его природных популяциях. Мейоспоры — споры полового размножения. Они образуются при прорастании зиготы — клетки, возникшей при половом процессе из двух родительских клеток. При прорастании зиготы и образовании спор полового размножения происходит перераспределение (рекомбинация) признаков родительских форм и увеличивается разнообразие. Так выглядит спора гриба под электронным сканирующим микроскопом, увеличенная в 20 тыс. раз
В жизненном цикле многих грибов образуются и митоспоры, и мейоспоры. Например, у многих сумчатых грибов — возбудителей мучнистой росы растений, парши яблок и груш, спорыньи и др. митоспоры образуются в течение периода вегетации и служат для повторного заражения растений, а мейоспоры — после перезимовки и вызывают первичное заражение растений. Однако у многочисленных грибов митоспоры в цикле развития отсутствуют. Нет их у большинства шляпочных грибов, гастеромицетов, трутовиков, многих дискомицетов, например сморчков и строчков, и др. В этих случаях мейоспоры принимают на себя функции митоспор — служат для массового расселения грибов. Известна и большая группа грибов, называемых дейтеромицетами (около 30 000 видов), у которых, наоборот, полностью утрачена способность к половому размножению и образуются только митоспоры.
Митоспоры образуются у грибов внутри специальных клеток — спорангиев или на веточках воздушного мицелия. Первые носят название спорангиоспоры и образуются путем раскалывания протопласта спорангия с многочисленными ядрами на одноядерные участки, каждый из которых затем превращается в спору. Митоспоры, образующиеся экзогенно (наружно) на веточках воздушного мицелия, называются конидиями.
Спорангиоспоры могут быть неподвижными и переноситься пассивно или имеют жгутики и активно движутся. Подвижные споры со жгутиками называют зооспорами. Зооспора представляет собой комочек протоплазмы, лишенный жесткой клеточной стенки и снабженный одним или двумя жгутиками. Они существуют совсем недолго, от нескольких минут до нескольких часов, и сохраняют жизнеспособность только в воде. Поэтому размножение зооспорами может происходить только в присутствии капельно-жидкой среды и дает преимущества только при обитании в воде. Проплавав определенное время, зооспора оседает на подходящий субстрат и прорастает в новое вегетативное тело. Зооспоры способны активно перемещаться лишь на небольшие расстояния (до 10 см) и с относительно небольшой скоростью, поэтому в их распространении большое значение имеет и пассивный перенос их токами воды. Однако для многих грибов — паразитов растений, размножающихся зооспорами, способность последних к активному движению даже на небольшие расстояния очень важна для заражения хозяина. Их зооспоры обладают положительным хемотаксисом — способностью активно двигаться по направлению к выделениям корней хозяев, содержащим аминокислоты, сахара и другие вещества. В результате такого движения зооспоры скапливаются у корней хозяина и вызывают их заражение. Особенно часто это наблюдается у различных паразитов на корнях растений, например у питиумов, ольпидиума капустного — возбудителя "черной ножки" рассады капусты и др.
Размножение зооспорами мы встречаем у всех групп первично водных грибов. У наземных грибов способность к их образованию постепенно утрачивается.
Так выглядит спора гриба под электронным сканирующим микроскопом, увеличенная в 20 тыс. раз
В жизненном цикле многих грибов образуются и митоспоры, и мейоспоры. Например, у многих сумчатых грибов — возбудителей мучнистой росы растений, парши яблок и груш, спорыньи и др. митоспоры образуются в течение периода вегетации и служат для повторного заражения растений, а мейоспоры — после перезимовки и вызывают первичное заражение растений. Однако у многочисленных грибов митоспоры в цикле развития отсутствуют. Нет их у большинства шляпочных грибов, гастеромицетов, трутовиков, многих дискомицетов, например сморчков и строчков, и др. В этих случаях мейоспоры принимают на себя функции митоспор — служат для массового расселения грибов. Известна и большая группа грибов, называемых дейтеромицетами (около 30 000 видов), у которых, наоборот, полностью утрачена способность к половому размножению и образуются только митоспоры.
Митоспоры образуются у грибов внутри специальных клеток — спорангиев или на веточках воздушного мицелия. Первые носят название спорангиоспоры и образуются путем раскалывания протопласта спорангия с многочисленными ядрами на одноядерные участки, каждый из которых затем превращается в спору. Митоспоры, образующиеся экзогенно (наружно) на веточках воздушного мицелия, называются конидиями.
Спорангиоспоры могут быть неподвижными и переноситься пассивно или имеют жгутики и активно движутся. Подвижные споры со жгутиками называют зооспорами. Зооспора представляет собой комочек протоплазмы, лишенный жесткой клеточной стенки и снабженный одним или двумя жгутиками. Они существуют совсем недолго, от нескольких минут до нескольких часов, и сохраняют жизнеспособность только в воде. Поэтому размножение зооспорами может происходить только в присутствии капельно-жидкой среды и дает преимущества только при обитании в воде. Проплавав определенное время, зооспора оседает на подходящий субстрат и прорастает в новое вегетативное тело. Зооспоры способны активно перемещаться лишь на небольшие расстояния (до 10 см) и с относительно небольшой скоростью, поэтому в их распространении большое значение имеет и пассивный перенос их токами воды. Однако для многих грибов — паразитов растений, размножающихся зооспорами, способность последних к активному движению даже на небольшие расстояния очень важна для заражения хозяина. Их зооспоры обладают положительным хемотаксисом — способностью активно двигаться по направлению к выделениям корней хозяев, содержащим аминокислоты, сахара и другие вещества. В результате такого движения зооспоры скапливаются у корней хозяина и вызывают их заражение. Особенно часто это наблюдается у различных паразитов на корнях растений, например у питиумов, ольпидиума капустного — возбудителя "черной ножки" рассады капусты и др.
Размножение зооспорами мы встречаем у всех групп первично водных грибов. У наземных грибов способность к их образованию постепенно утрачивается.
 Типы бесполового размножения у грибов: 1 — зооспорангий с зооспорами; 2 — спорангий со спорангиоспорами; 3 — конидиеносец с конидиями
Одна из наиболее интересных в биологическом отношении групп грибов — пероно-споровые. В этой группе, происшедшей от водных грибов, только немногие ее представители связаны сейчас с водной средой, а большинство других — наземные организмы, преимущественно паразиты цветковых растений. Поэтому в ней хорошо прослеживаются те изменения, которые произошли у грибов при выходе их на сушу. У многих наземных грибов из пероноспоровых сохранилось еще размножение зооспорами, но у них возникли и многочисленные приспособления для распространения в воздушной среде. Так, зооспорангий у них не прорастает на месте его образования, как это происходит у водных грибов, а отделяется от спорангиеносца и переносится целиком, как конидия, ветром или каплями дождя. Зооспоры выходят из такого зооспорангия только в присутствии капельно-жидкой воды и при пониженной температуре воздуха, а при повышенной температуре в сухую погоду зооспорангий прорастает непосредственно ростковой трубкой. Это наблюдается, например, у фитофторы — возбудителя фитофтороза у картофеля и томатов.
У мукоровых грибов, образующих неподвижные спорангиоспоры, число их в одном спорангии колеблется от одной до 70 000 тысяч в больших спорангиях, диаметром до 1,5 мм, например у фикомицеса Блексли. Увеличение продукции спорангиоспор достигается у них также ветвлением спорангиеносцев и соответственно увеличением числа спорангиев. Спорангиоспоры, как и зооспоры, служат только для расселения грибов, они содержат мало питательных веществ и не способны сохранять жизнеспособность в течение длительного времени. Кроме того, для образования большого спорангия с многочисленными спорангиоспорами нужно значительно больше времени, чем для массового образования конидий. Поэтому у большинства грибов получило распространение бесполое размножение при помощи конидий.
Типы бесполового размножения у грибов: 1 — зооспорангий с зооспорами; 2 — спорангий со спорангиоспорами; 3 — конидиеносец с конидиями
Одна из наиболее интересных в биологическом отношении групп грибов — пероно-споровые. В этой группе, происшедшей от водных грибов, только немногие ее представители связаны сейчас с водной средой, а большинство других — наземные организмы, преимущественно паразиты цветковых растений. Поэтому в ней хорошо прослеживаются те изменения, которые произошли у грибов при выходе их на сушу. У многих наземных грибов из пероноспоровых сохранилось еще размножение зооспорами, но у них возникли и многочисленные приспособления для распространения в воздушной среде. Так, зооспорангий у них не прорастает на месте его образования, как это происходит у водных грибов, а отделяется от спорангиеносца и переносится целиком, как конидия, ветром или каплями дождя. Зооспоры выходят из такого зооспорангия только в присутствии капельно-жидкой воды и при пониженной температуре воздуха, а при повышенной температуре в сухую погоду зооспорангий прорастает непосредственно ростковой трубкой. Это наблюдается, например, у фитофторы — возбудителя фитофтороза у картофеля и томатов.
У мукоровых грибов, образующих неподвижные спорангиоспоры, число их в одном спорангии колеблется от одной до 70 000 тысяч в больших спорангиях, диаметром до 1,5 мм, например у фикомицеса Блексли. Увеличение продукции спорангиоспор достигается у них также ветвлением спорангиеносцев и соответственно увеличением числа спорангиев. Спорангиоспоры, как и зооспоры, служат только для расселения грибов, они содержат мало питательных веществ и не способны сохранять жизнеспособность в течение длительного времени. Кроме того, для образования большого спорангия с многочисленными спорангиоспорами нужно значительно больше времени, чем для массового образования конидий. Поэтому у большинства грибов получило распространение бесполое размножение при помощи конидий.
 Конидиальное спороношение мучнисторосяного гриба
Образование конидий характерно для грибов с клеточным мицелием, так называемых высших грибов. Конидии образуются на гифах воздушного мицелия, обычно на специализированных веточках — конидиеносцах. Они могут быть очень мелкими, размером от 1 до 10-15 мкм, и формироваться в огромных количествах. Так, одна колония пеницилла (зеленой плесени) диаметром не более 3 см образует около 4-Ю8 конидий. У других грибов конидии размером до 50-100 мк и более. Такие конидии часто многоклеточные, толстостенные, содержат в клеточных стенках темные пигменты — меланины. В отличие от спорангиоспор конидии грибов могут часто длительно сохранять жизнеспособность при неблагоприятных условиях, не прорастая.
Конидиеносцы образуются непосредственно на воздушном мицелии поодиночке, как его веточки, или собраны в большие группы. У цератоцистиса вязового — возбудителя голландской болезни вязов конидиеносцы срастаются в длинный столбик, на вершине которого образуются конидии. Нектрия киноварно-красная, часто встречающаяся на ветках различных лиственных деревьев и кустарников, образует розовые подушечки плотно собранных конидиеносцев. У некоторых паразитов растений конидиеносцы собраны плотным слоем под кутикулой или эпидермисом пораженных листьев. Наконец, конидиеносцы могут развиваться внутри специальных, обычно шаровидных или грушевидных вместилищ, имеющих на вершине отверстие, через которое освобождаются конидии. Они обеспечивают не только массовую продукцию конидий, но и защищают развивающиеся конидиеносцы и конидии от неблагоприятных воздействий внешней среды.
Освобождение конидий происходит, как правило, пассивно, хотя у некоторых грибов — нигроспоры, дейгтониеллы и др. — наблюдается активное их отбрасывание. У конидий возникли и многочисленные адаптации, облегчающие их распространение. Некоторые конидии имеют сухую, плохо смачивающуюся поверхность и легко переносятся токами воздуха, другие погружены в слизь и переносятся водой или насекомыми. У грибов, вторично перешедших к обитанию в водной среде, конидии часто приобретают причудливую форму — тетрарадиальную, извитую, спиральную и т. п. Такая форма обеспечивает длительное парение конидий в толще воды, они не тонут и переносятся токами воды на большие расстояния.
Мейоспоры грибов, как и митоспоры, тоже крайне разнообразны. У грибов, образующих спорангиоспоры, споры полового размножения также образуются в специальных спорангиях — зародышевых. Но у большей части известных сейчас грибов (более чем у 60 000 видов) мейоспоры образуются внутри или на поверхности специальных клеток, называемых соответственно сумками и базидиями.
Рассматривая под микроскопом тонкий срез сморчка, строчка или чашечку пецицы, можно увидеть довольно правильный слой, состоящий из удлиненных клеток и расположенных между ними более тонких, нитевидных гиф. Если плодовое тело было зрелым, в удлиненных цилиндрических клетках будет видно по 8 спор, расположенных в один ряд. Эти цилиндрические клетки и называют сумками или асками, а образующиеся в них мейоспоры — сумкоспорами или аскоспорами. Образование сумок характерно для очень большой группы грибов — класса аскомицетов, или сумчатых. Однако далеко не у всех из них образуются такие крупные и хорошо развитые плодовые тела, как у сморчков и строчков. У наиболее примитивных аскомицетов сумки появляются прямо на мицелии, а аскоспоры освобождаются из них пассивно после разрыва или расплывания оболочки сумки.
В процессе эволюции у аскомицетов возникли плодовые тела, сначала очень мелкие и примитивные, с беспорядочно разбросанными внутри них сумками, а затем все более и более совершенные, в которых сумки располагались правильным слоем — гимением. В плодовых телах сумки хорошо защищены, особенно на ранних стадиях их развития, от влияния неблагоприятных факторов среды — высушивания, излишней инсоляции, колебания температуры и т. п. В процессе эволюции аскомицеты стали активно выбрасывать аскоспоры из сумок. Аскоспоры в сумке окружены не использованной на их формирование цитоплазмой. К моменту созревания аскоспор в ней происходит превращение гликогена в сахар, тургорное давление в сумке резко возрастает, оболочка ее разрывается и аскоспоры с силой выбрасываются на расстояние от десятых долей миллиметра до нескольких десятков сантиметров.
У аскомицетов известно несколько типов плодовых тел. Наиболее примитивные из них — клейстотеции. Они имеют обычно шаровидную или сплюснутую форму, полностью замкнуты, и размеры их невелики, 100-500 мкм в диаметре, реже крупнее. В культуре на питательных средах или в природе их часто можно заметить невооруженным глазом в виде маленьких, различной окраски шариков — белых, желтых, оранжевых, бурых или черных.
Более совершенный тип плодового тела — перитеций. Это полузамкнутое плодовое тело, большей частью кувшинообразное или округлое, с узким выводным отверстием на вершине, на дне расположены пучком или слоем сумки и стерильные гифы — парафизы. Аскоспоры выбрасываются из перитеция обычно активно. Этот процесс детально описан у многих аскомицетов. У сордарии, например, обильно развивающейся на навозе травоядных животных, сумки, удлиняясь за счет растяжения или роста, поочередно достигают отверстия перитеция и выбрасывают аскоспоры на расстояние до 20 см. У некоторых грибов, имеющих перитеции с очень длинной шейкой, например у эндотии, вызывающей серьезное заболевание каштанов, сумки имеют быстро растворяющуюся ножку и после созревания свободно лежат в слизи в полости перитеция. При набухании сумок в перитеции создается давление, и они поочередно выталкиваются к отверстию, выбрасывая аскоспоры. За час из перитеция выбрасывается около 14 000 аскоспор.
Конидиальное спороношение мучнисторосяного гриба
Образование конидий характерно для грибов с клеточным мицелием, так называемых высших грибов. Конидии образуются на гифах воздушного мицелия, обычно на специализированных веточках — конидиеносцах. Они могут быть очень мелкими, размером от 1 до 10-15 мкм, и формироваться в огромных количествах. Так, одна колония пеницилла (зеленой плесени) диаметром не более 3 см образует около 4-Ю8 конидий. У других грибов конидии размером до 50-100 мк и более. Такие конидии часто многоклеточные, толстостенные, содержат в клеточных стенках темные пигменты — меланины. В отличие от спорангиоспор конидии грибов могут часто длительно сохранять жизнеспособность при неблагоприятных условиях, не прорастая.
Конидиеносцы образуются непосредственно на воздушном мицелии поодиночке, как его веточки, или собраны в большие группы. У цератоцистиса вязового — возбудителя голландской болезни вязов конидиеносцы срастаются в длинный столбик, на вершине которого образуются конидии. Нектрия киноварно-красная, часто встречающаяся на ветках различных лиственных деревьев и кустарников, образует розовые подушечки плотно собранных конидиеносцев. У некоторых паразитов растений конидиеносцы собраны плотным слоем под кутикулой или эпидермисом пораженных листьев. Наконец, конидиеносцы могут развиваться внутри специальных, обычно шаровидных или грушевидных вместилищ, имеющих на вершине отверстие, через которое освобождаются конидии. Они обеспечивают не только массовую продукцию конидий, но и защищают развивающиеся конидиеносцы и конидии от неблагоприятных воздействий внешней среды.
Освобождение конидий происходит, как правило, пассивно, хотя у некоторых грибов — нигроспоры, дейгтониеллы и др. — наблюдается активное их отбрасывание. У конидий возникли и многочисленные адаптации, облегчающие их распространение. Некоторые конидии имеют сухую, плохо смачивающуюся поверхность и легко переносятся токами воздуха, другие погружены в слизь и переносятся водой или насекомыми. У грибов, вторично перешедших к обитанию в водной среде, конидии часто приобретают причудливую форму — тетрарадиальную, извитую, спиральную и т. п. Такая форма обеспечивает длительное парение конидий в толще воды, они не тонут и переносятся токами воды на большие расстояния.
Мейоспоры грибов, как и митоспоры, тоже крайне разнообразны. У грибов, образующих спорангиоспоры, споры полового размножения также образуются в специальных спорангиях — зародышевых. Но у большей части известных сейчас грибов (более чем у 60 000 видов) мейоспоры образуются внутри или на поверхности специальных клеток, называемых соответственно сумками и базидиями.
Рассматривая под микроскопом тонкий срез сморчка, строчка или чашечку пецицы, можно увидеть довольно правильный слой, состоящий из удлиненных клеток и расположенных между ними более тонких, нитевидных гиф. Если плодовое тело было зрелым, в удлиненных цилиндрических клетках будет видно по 8 спор, расположенных в один ряд. Эти цилиндрические клетки и называют сумками или асками, а образующиеся в них мейоспоры — сумкоспорами или аскоспорами. Образование сумок характерно для очень большой группы грибов — класса аскомицетов, или сумчатых. Однако далеко не у всех из них образуются такие крупные и хорошо развитые плодовые тела, как у сморчков и строчков. У наиболее примитивных аскомицетов сумки появляются прямо на мицелии, а аскоспоры освобождаются из них пассивно после разрыва или расплывания оболочки сумки.
В процессе эволюции у аскомицетов возникли плодовые тела, сначала очень мелкие и примитивные, с беспорядочно разбросанными внутри них сумками, а затем все более и более совершенные, в которых сумки располагались правильным слоем — гимением. В плодовых телах сумки хорошо защищены, особенно на ранних стадиях их развития, от влияния неблагоприятных факторов среды — высушивания, излишней инсоляции, колебания температуры и т. п. В процессе эволюции аскомицеты стали активно выбрасывать аскоспоры из сумок. Аскоспоры в сумке окружены не использованной на их формирование цитоплазмой. К моменту созревания аскоспор в ней происходит превращение гликогена в сахар, тургорное давление в сумке резко возрастает, оболочка ее разрывается и аскоспоры с силой выбрасываются на расстояние от десятых долей миллиметра до нескольких десятков сантиметров.
У аскомицетов известно несколько типов плодовых тел. Наиболее примитивные из них — клейстотеции. Они имеют обычно шаровидную или сплюснутую форму, полностью замкнуты, и размеры их невелики, 100-500 мкм в диаметре, реже крупнее. В культуре на питательных средах или в природе их часто можно заметить невооруженным глазом в виде маленьких, различной окраски шариков — белых, желтых, оранжевых, бурых или черных.
Более совершенный тип плодового тела — перитеций. Это полузамкнутое плодовое тело, большей частью кувшинообразное или округлое, с узким выводным отверстием на вершине, на дне расположены пучком или слоем сумки и стерильные гифы — парафизы. Аскоспоры выбрасываются из перитеция обычно активно. Этот процесс детально описан у многих аскомицетов. У сордарии, например, обильно развивающейся на навозе травоядных животных, сумки, удлиняясь за счет растяжения или роста, поочередно достигают отверстия перитеция и выбрасывают аскоспоры на расстояние до 20 см. У некоторых грибов, имеющих перитеции с очень длинной шейкой, например у эндотии, вызывающей серьезное заболевание каштанов, сумки имеют быстро растворяющуюся ножку и после созревания свободно лежат в слизи в полости перитеция. При набухании сумок в перитеции создается давление, и они поочередно выталкиваются к отверстию, выбрасывая аскоспоры. За час из перитеция выбрасывается около 14 000 аскоспор.
 У сумчатого гриба ксилярии перитеции образуются на стромах и в них содержится масса сумок с аскоспорами
Наиболее совершенный тип плодового тела у аскомицетов — апотеций. Это широкораскрытые при созревании плодовые тела, большей частью блюдцевидные, чашевидные, бокаловидные или дисковидные. Их верхняя сторона — диск — выстлана гимением, состоящим из сумок и парафиз. Аскоспоры из апотециев выбрасываются активно. Расположение сумок широко открытым гимением дает возможность одновременного выбрасывания аскоспор из многих сумок в виде взрыва или залпа. При прикосновении к крупным апотециям пецицы или других дискомицетов часто можно увидеть над ними легкое облачко выброшенных аскоспор и даже слышать характерный щелчок. Аскоспоры выбрасываются из апотециев на расстояние от 0,5 до 20, а у некоторых видов до 60 см. Иногда строение апотециев отличается от типичного, чашевидного. Они бывают булавовидные у геоглоссума, часто встречающегося в хвойно-широколиственных лесах, имеют вид лопаточки у спатулярии, шляпки с закрученным краем на ножке у кудонии, обычной в наших еловых или смешанных лесах. У сморчков, строчков и сморчковой шапочки апотеций дифференцированы на шляпку и ножку, а клубневидные апотеции трюфелей вторично замкнуты в связи с обитанием под землей. Апотеции — самые крупные плодовые тела у аскомицетов, их размеры — от долей миллиметра до 15-20 см, а иногда и крупнее.
У сумчатого гриба ксилярии перитеции образуются на стромах и в них содержится масса сумок с аскоспорами
Наиболее совершенный тип плодового тела у аскомицетов — апотеций. Это широкораскрытые при созревании плодовые тела, большей частью блюдцевидные, чашевидные, бокаловидные или дисковидные. Их верхняя сторона — диск — выстлана гимением, состоящим из сумок и парафиз. Аскоспоры из апотециев выбрасываются активно. Расположение сумок широко открытым гимением дает возможность одновременного выбрасывания аскоспор из многих сумок в виде взрыва или залпа. При прикосновении к крупным апотециям пецицы или других дискомицетов часто можно увидеть над ними легкое облачко выброшенных аскоспор и даже слышать характерный щелчок. Аскоспоры выбрасываются из апотециев на расстояние от 0,5 до 20, а у некоторых видов до 60 см. Иногда строение апотециев отличается от типичного, чашевидного. Они бывают булавовидные у геоглоссума, часто встречающегося в хвойно-широколиственных лесах, имеют вид лопаточки у спатулярии, шляпки с закрученным краем на ножке у кудонии, обычной в наших еловых или смешанных лесах. У сморчков, строчков и сморчковой шапочки апотеций дифференцированы на шляпку и ножку, а клубневидные апотеции трюфелей вторично замкнуты в связи с обитанием под землей. Апотеции — самые крупные плодовые тела у аскомицетов, их размеры — от долей миллиметра до 15-20 см, а иногда и крупнее.
 Чашевидный у пецицы
Часто плодовые тела образуются не на мицелии, а на его более или менее массивных сплетениях — стромах, имеющих различные размеры, окраску и консистенцию. На стволах и ветвях лиственных деревьев, особенно березы, можно встретить довольно крупные (до 4 см и более) полушаровидные или шаровидные углистые стромы дальдинии концентрической. На их разломе хорошо видны концентрические кольца. На поверхности стромы образуются перитеции, погруженные в нее по самый носик. После созревания и выбрасывания из них аскоспор нарастает новый слой стромы и в нем снова образуются перитеции. Этот процесс повторяется многократно и приводит к образованию слоистости.
Чашевидный у пецицы
Часто плодовые тела образуются не на мицелии, а на его более или менее массивных сплетениях — стромах, имеющих различные размеры, окраску и консистенцию. На стволах и ветвях лиственных деревьев, особенно березы, можно встретить довольно крупные (до 4 см и более) полушаровидные или шаровидные углистые стромы дальдинии концентрической. На их разломе хорошо видны концентрические кольца. На поверхности стромы образуются перитеции, погруженные в нее по самый носик. После созревания и выбрасывания из них аскоспор нарастает новый слой стромы и в нем снова образуются перитеции. Этот процесс повторяется многократно и приводит к образованию слоистости.
 В виде шляпки на ножке у леотии
Совсем иное строение и вид имеют стромы у спорыньи. Склероции этого гриба после перезимовки прорастают головчатыми стромами красноватого цвета с головкой диаметром 1 -1,5 мм. По периферии головки стромы развиваются перитеции. А у циттарий, обитающих в Южном полушарии на деревьях из рода нотофагус, образуются плотные группы крупных стром желтоватого или оранжевого цвета, на которых появляются многочисленные апотеции. Ч. Дарвин первый обратил внимание на эти интересные и необычные грибы, в массе встречающиеся в лесах Южной Америки, и описал их в своем "Путешествии натуралиста вокруг света". Он отметил также, что на Огненной Земле местные жители собирают зрелые стромы этих грибов и едят их сырыми. Стромы имеют сладковатый вкус, а по запаху напоминают шампиньоны.
В виде шляпки на ножке у леотии
Совсем иное строение и вид имеют стромы у спорыньи. Склероции этого гриба после перезимовки прорастают головчатыми стромами красноватого цвета с головкой диаметром 1 -1,5 мм. По периферии головки стромы развиваются перитеции. А у циттарий, обитающих в Южном полушарии на деревьях из рода нотофагус, образуются плотные группы крупных стром желтоватого или оранжевого цвета, на которых появляются многочисленные апотеции. Ч. Дарвин первый обратил внимание на эти интересные и необычные грибы, в массе встречающиеся в лесах Южной Америки, и описал их в своем "Путешествии натуралиста вокруг света". Он отметил также, что на Огненной Земле местные жители собирают зрелые стромы этих грибов и едят их сырыми. Стромы имеют сладковатый вкус, а по запаху напоминают шампиньоны.
 Алеврия оранжевая
Для того чтобы увидеть базидии, нужно взять плодовое тело любого шляпочного гриба и отделить от него одну из пластинок или часть трубочек, расположенных на нижней поверхности шляпки. На поперечном срезе пластинки или трубочки под микроскопом виден, как и у дискомицетов, гимений, покрывающий поверхность пластинок или выстилающий полость трубочек. Однако у шляпочных грибов он выглядит иначе. Споры располагаются не внутри клеток, как у сумчатых грибов, а на поверхности булавовидных клеток, на выростах — стеригмах. На каждой такой клетке (базидии) образуется обычно по 4 базидиоспоры. Кроме базидий, в гимении можно видеть и другие элементы, например цистиды различной формы, выступающие над слоем базидий и защищающие его от соприкосновения с соседними пластинками и другими поверхностями.
Алеврия оранжевая
Для того чтобы увидеть базидии, нужно взять плодовое тело любого шляпочного гриба и отделить от него одну из пластинок или часть трубочек, расположенных на нижней поверхности шляпки. На поперечном срезе пластинки или трубочки под микроскопом виден, как и у дискомицетов, гимений, покрывающий поверхность пластинок или выстилающий полость трубочек. Однако у шляпочных грибов он выглядит иначе. Споры располагаются не внутри клеток, как у сумчатых грибов, а на поверхности булавовидных клеток, на выростах — стеригмах. На каждой такой клетке (базидии) образуется обычно по 4 базидиоспоры. Кроме базидий, в гимении можно видеть и другие элементы, например цистиды различной формы, выступающие над слоем базидий и защищающие его от соприкосновения с соседними пластинками и другими поверхностями.
 Базидии образуют плотный слой на пластинках шляпочного гриба
Базидии образуются у большой группы базидиальных грибов, или базидиемицетов, насчитывающей около 30 000 видов, однако не у всех они развиваются на сложно устроенных плодовых телах. У немногих из них базидии образуются непосредственно на мицелии (например, у экзобазидиума, дающего белые или розоватые пятна на деформированных листьях брусники). У головневых и ржавчинных грибов, паразитирующих на растениях, формируются покоящиеся споры, которые после перезимовки прорастают базидией. Плодовые тела того или иного строения имеются у большинства базидиомицетов, причем крайне разнообразные. Они могут иметь вид рыхлого прижатого налета или распростертых корочек разного цвета, встречающихся чаще всего на древесине, реже на почве и остатках травянистых растений. Гимений расположен у них на верхней стороне. Часто встречаются плодовые тела в виде палочек или булав, разветвленных кустиков, растущих на почве. На деревьях и гниющей древесине можно видеть плодовые тела копытообразные или в виде боковых черепитчато расположенных шляпок, коралловидно-разветвленные и т. д. Встречаются шляпочные грибы, плодовые тела которых состоят из шляпки и ножки.
Базидии образуют плотный слой на пластинках шляпочного гриба
Базидии образуются у большой группы базидиальных грибов, или базидиемицетов, насчитывающей около 30 000 видов, однако не у всех они развиваются на сложно устроенных плодовых телах. У немногих из них базидии образуются непосредственно на мицелии (например, у экзобазидиума, дающего белые или розоватые пятна на деформированных листьях брусники). У головневых и ржавчинных грибов, паразитирующих на растениях, формируются покоящиеся споры, которые после перезимовки прорастают базидией. Плодовые тела того или иного строения имеются у большинства базидиомицетов, причем крайне разнообразные. Они могут иметь вид рыхлого прижатого налета или распростертых корочек разного цвета, встречающихся чаще всего на древесине, реже на почве и остатках травянистых растений. Гимений расположен у них на верхней стороне. Часто встречаются плодовые тела в виде палочек или булав, разветвленных кустиков, растущих на почве. На деревьях и гниющей древесине можно видеть плодовые тела копытообразные или в виде боковых черепитчато расположенных шляпок, коралловидно-разветвленные и т. д. Встречаются шляпочные грибы, плодовые тела которых состоят из шляпки и ножки.
 Шляпочные грибы спороносят так обильно, что часто покрывают своими спорами окружающие их растения и почву
Все плодовые тела имеют разнообразную окраску и консистенцию, но при всем их разнообразии их объединяет одно — базидии образуют на всей поверхности плодового тела или части его (гименофоре) гимений, расположенный, как правило, открыто. Поэтому группа базидиомицетов с таким типом плодового тела получила название гименомицетов в отличие от гастеромицетов, у которых плодовые тела замкнуты до полового созревания базидио-спор. У последних базидии располагаются внутри плодового тела, там образуют базидиоспоры, а освобождение базидиоспор происходит уже после их отделения от базидий.
Шляпочные грибы спороносят так обильно, что часто покрывают своими спорами окружающие их растения и почву
Все плодовые тела имеют разнообразную окраску и консистенцию, но при всем их разнообразии их объединяет одно — базидии образуют на всей поверхности плодового тела или части его (гименофоре) гимений, расположенный, как правило, открыто. Поэтому группа базидиомицетов с таким типом плодового тела получила название гименомицетов в отличие от гастеромицетов, у которых плодовые тела замкнуты до полового созревания базидио-спор. У последних базидии располагаются внутри плодового тела, там образуют базидиоспоры, а освобождение базидиоспор происходит уже после их отделения от базидий.
 Споры шляпочных грибов разнообразны по форме и окраске
Эволюция плодовых тел гименомицетов шла, как и у других грибов, в направлении увеличения споровой продукции и совершенствования способов их распространения. Это особенно важно у гименомицетов, которые, как правило, не образуют митоспор, поэтому для расселения гриба служат базидиоспоры.
Споры шляпочных грибов разнообразны по форме и окраске
Эволюция плодовых тел гименомицетов шла, как и у других грибов, в направлении увеличения споровой продукции и совершенствования способов их распространения. Это особенно важно у гименомицетов, которые, как правило, не образуют митоспор, поэтому для расселения гриба служат базидиоспоры.
 Ежевиковый гриб
У многих базидиомицетов мицелий живет долго, часто много лет, и на нем каждый год или реже образуются плодовые тела с базидиоспорами, а у некоторых трутовиков и плодовые тела многолетние. Если одно плодовое тело красного мухомора за 5-6 дней своего существования образует до 575 млрд. спор, а на каждом мицелии ежегодно плодовых тел образуется несколько, можно представить, как велика споровая продукция одного мицелия мухомора за всю его жизнь.
Ежевиковый гриб
У многих базидиомицетов мицелий живет долго, часто много лет, и на нем каждый год или реже образуются плодовые тела с базидиоспорами, а у некоторых трутовиков и плодовые тела многолетние. Если одно плодовое тело красного мухомора за 5-6 дней своего существования образует до 575 млрд. спор, а на каждом мицелии ежегодно плодовых тел образуется несколько, можно представить, как велика споровая продукция одного мицелия мухомора за всю его жизнь.
 Аурискальпиум, растущий на сосновых шишках
Увеличение числа спор, образующихся на одном плодовом теле, достигается у гименомицетов увеличением его поверхности, несущей гимений, — гименофора. У рогатиковых грибов с гладким гименофором происходит сильное расчленение и ветвление всего плодового тела, например у многочисленных рамарий, клавикороны, спарассиса — "грибной капусты" и других представителейэтой группы.
Аурискальпиум, растущий на сосновых шишках
Увеличение числа спор, образующихся на одном плодовом теле, достигается у гименомицетов увеличением его поверхности, несущей гимений, — гименофора. У рогатиковых грибов с гладким гименофором происходит сильное расчленение и ветвление всего плодового тела, например у многочисленных рамарий, клавикороны, спарассиса — "грибной капусты" и других представителейэтой группы.
 Пластинцатый шляпочный гриб
У большинства же гименомицетов эволюция пошла по другому пути, пути совершенствования гименофора. Вместо гладкого гименофора у многих из них сформировался гименофор различного строения — складчатый (например, у настоящего домового гриба и у лисички), в виде разнообразных шипиков, гребенчатых пластин — у ежевиковых (ежевика желтого, герициума коралловидного и др.), трубочек разной длины и диаметра, внутренняя поверхность которых выстлана гимением, — у многочисленных трутовых и некоторых шляпочных грибов и, наконец, в виде пластинок, поверхность которых покрывает гимений, — у большинства шляпочных грибов. В результате увеличения гименофора многие гименомицеты образуют огромные количества спор.
Пластинцатый шляпочный гриб
У большинства же гименомицетов эволюция пошла по другому пути, пути совершенствования гименофора. Вместо гладкого гименофора у многих из них сформировался гименофор различного строения — складчатый (например, у настоящего домового гриба и у лисички), в виде разнообразных шипиков, гребенчатых пластин — у ежевиковых (ежевика желтого, герициума коралловидного и др.), трубочек разной длины и диаметра, внутренняя поверхность которых выстлана гимением, — у многочисленных трутовых и некоторых шляпочных грибов и, наконец, в виде пластинок, поверхность которых покрывает гимений, — у большинства шляпочных грибов. В результате увеличения гименофора многие гименомицеты образуют огромные количества спор.
 Рогатики и экзобазидиум на листьях брусники
Рогатики и экзобазидиум на листьях брусники
 Рогатики и экзобазидиум на стеблях брусники
Если мы отрежем шляпку у шляпочного гриба, положим ее на белую или черную бумагу (в зависимости от окраски пластинок или трубочек) и покроем стеклянным колпаком или банкой, то уже через несколько часов на бумаге можно будет видеть массу спор гриба (споровый порошок), образующих рисунок, точно соответствующий расположению элементов гименофора. Споровый порошок часто можно увидеть и в природе, например на шляпках осенних опенков, расположенных в группах под другими плодовыми телами.
Рогатики и экзобазидиум на стеблях брусники
Если мы отрежем шляпку у шляпочного гриба, положим ее на белую или черную бумагу (в зависимости от окраски пластинок или трубочек) и покроем стеклянным колпаком или банкой, то уже через несколько часов на бумаге можно будет видеть массу спор гриба (споровый порошок), образующих рисунок, точно соответствующий расположению элементов гименофора. Споровый порошок часто можно увидеть и в природе, например на шляпках осенних опенков, расположенных в группах под другими плодовыми телами.
 Тип гименофор базидиальных грибов (шиповидный)
При массовом освобождении базидиоспоры заносятся конвекционными токами воздуха на поверхность шляпки того же плодового тела. Это можно наблюдать, например, у сыроежек с красной или темной окраской шляпки или у плоского трутовика. Среднее плодовое тело навозника образует более миллиарда базидиоспор, а лишь на 1 см2 плодового тела настоящего домового гриба за сутки образуется до 35 млн. спор. Освобождение базидиоспор происходит путем их активного отбрасывания от базидии.
Тип гименофор базидиальных грибов (шиповидный)
При массовом освобождении базидиоспоры заносятся конвекционными токами воздуха на поверхность шляпки того же плодового тела. Это можно наблюдать, например, у сыроежек с красной или темной окраской шляпки или у плоского трутовика. Среднее плодовое тело навозника образует более миллиарда базидиоспор, а лишь на 1 см2 плодового тела настоящего домового гриба за сутки образуется до 35 млн. спор. Освобождение базидиоспор происходит путем их активного отбрасывания от базидии.
 Тип гименофор базидиальных грибов (трубчатый)
В основе этого процесса, как и при выбрасывании аскоспор из сумок, лежит гидролиз гликогена и повышение осмотического давления внутри базидии. Через канал стеригмы давление передается базидиоспоре и она, получив толчок, отбрасывается на небольшое расстояние, обычно в доли миллиметра, а затем переносится токами воздуха.
Тип гименофор базидиальных грибов (трубчатый)
В основе этого процесса, как и при выбрасывании аскоспор из сумок, лежит гидролиз гликогена и повышение осмотического давления внутри базидии. Через канал стеригмы давление передается базидиоспоре и она, получив толчок, отбрасывается на небольшое расстояние, обычно в доли миллиметра, а затем переносится токами воздуха.
 Тип гименофор базидиальных грибов (пластинчатый)
В процессе эволюции плодовых тел у гименомицетов наблюдается перенос гименофора с верхней поверхности плодового тела (так он расположен на распростертых по субстрату плодовых телах) на его нижнюю поверхность (у плодовых тел, прикрепленных к субстрату боком, например у трутовиков, и шляпочных грибов). В этом случае после активного отбрасывания базидиоспоры начинается ее свободное падение, скорость которого зависит от массы споры. У шампиньона базидиоспора падает со скоростью 1 мм/с, а у других грибов — до 3 мм/с, Достаточно продолжительный период свободного падения базидиоспор значительно повышает вероятность переноса их токами воздуха. Однако в этом случае очень важной оказывается правильная, строго вертикальная ориентация трубочек или пластинок по отношению к поверхности земли, так как даже при небольшом их наклоне большая часть базидиоспор попадет на соседнюю пластинку или останется в трубочке. Но этого не происходит, так как плодовым телам гименомицетов свойствен геотропизм, обусловленный земным тяготением: их гименофор всегда ориентирован правильно.
Тип гименофор базидиальных грибов (пластинчатый)
В процессе эволюции плодовых тел у гименомицетов наблюдается перенос гименофора с верхней поверхности плодового тела (так он расположен на распростертых по субстрату плодовых телах) на его нижнюю поверхность (у плодовых тел, прикрепленных к субстрату боком, например у трутовиков, и шляпочных грибов). В этом случае после активного отбрасывания базидиоспоры начинается ее свободное падение, скорость которого зависит от массы споры. У шампиньона базидиоспора падает со скоростью 1 мм/с, а у других грибов — до 3 мм/с, Достаточно продолжительный период свободного падения базидиоспор значительно повышает вероятность переноса их токами воздуха. Однако в этом случае очень важной оказывается правильная, строго вертикальная ориентация трубочек или пластинок по отношению к поверхности земли, так как даже при небольшом их наклоне большая часть базидиоспор попадет на соседнюю пластинку или останется в трубочке. Но этого не происходит, так как плодовым телам гименомицетов свойствен геотропизм, обусловленный земным тяготением: их гименофор всегда ориентирован правильно.
 Споровые отпечатки
Очень четко геотропизм проявляется у трутовиков. Их многолетние плодовые тела часто развиваются на дереве, стоящем вертикально, и их трубочки направлены вниз. После того, как дерево упадет, трубочки оказываются направленными к земле боком и споры в них задерживаются и не выпадают. Такие трубочки быстро зарастают стерильным мицелием, а гименофор начинает развиваться на той части плодового тела, которая обращена к земле, или начинает формироваться новое, правильно сориентированное по отношению к земле плодовое тело.
Споровые отпечатки
Очень четко геотропизм проявляется у трутовиков. Их многолетние плодовые тела часто развиваются на дереве, стоящем вертикально, и их трубочки направлены вниз. После того, как дерево упадет, трубочки оказываются направленными к земле боком и споры в них задерживаются и не выпадают. Такие трубочки быстро зарастают стерильным мицелием, а гименофор начинает развиваться на той части плодового тела, которая обращена к земле, или начинает формироваться новое, правильно сориентированное по отношению к земле плодовое тело.
 Если плодовое тело шляпочного гриба развивается на пне или стволе дерева, его ножка изгибается и пластинки распологаются строго вертикально
Совершенствование формы плодовых тел гименомицетов сопровождалось и дифференциацией гиф, из сплетения которых они состоят. Если наиболее примитивные плодовые тела, например у кортициевых, обитающих на влажной древесине, ветках, в лесной подстилке, где они образуют рыхлые или кожистые пленки или корочки, состоят из однородных тонкостенных и обильно ветвящихся гиф, то у трутовиков с копытообразными плодовыми телами они сложены гифами двух или трех типов: кроме тонкостенных, в них можно видеть толстостенные, малоразветвленные скелетные гифы и такие же толстостенные, но обильно ветвящиеся связывающие гифы, выполняющие механические функции. В плодовых телах млечников имеются специальные гифы, содержащие млечный сок, — млечные ходы.
Пожалуй, наиболее распространенный тип плодового тела у гименомицетов — это шляпочный гриб, т. е. плодовое тело, состоящее из шляпки на ножке. Плодовые тела этого типа обычно имеют мягкомясистую консистенцию и быстро загнивают, реже они бывают восковатой или кожистой консистенции. У негниючников они не загнивают, о чем говорит само их название, а высыхают в сухую погоду, вновь оживая после дождя. У навозников плодовое тело в зрелом возрасте расплывается (автолизируется). Шляпка и ножка могут быть самой разнообразной формы, причем их форма всегда постоянна и характерна для того или иного вида. Шляпка покрыта сверху кожицей, окраска и характер которой разнообразны. Окраска ее обычно определяет окраску шляпки, а кожица может быть гладкой, бархатистой, чешуйчатой и т. д., сухой или слизистой — она защищает мякоть шляпки от высыхания и повреждений. Мякоть шляпки может иметь различную консистенцию от плотной до рыхлой и губчатой, окраска ее обычно светлая, белая, желтоватая, светло-охряная или буроватая, однако на разломе или разрезе у некоторых грибов. например синяка, подосиновика, поддубника и др., ее окраска меняется: мякоть синеет, краснеет и темнеет. В мякоти млечников — рыжиков, груздей и др. — содержится бесцветный, белый или яркоокрашенный млечный сок, который на воздухе может изменять окраску.
Если плодовое тело шляпочного гриба развивается на пне или стволе дерева, его ножка изгибается и пластинки распологаются строго вертикально
Совершенствование формы плодовых тел гименомицетов сопровождалось и дифференциацией гиф, из сплетения которых они состоят. Если наиболее примитивные плодовые тела, например у кортициевых, обитающих на влажной древесине, ветках, в лесной подстилке, где они образуют рыхлые или кожистые пленки или корочки, состоят из однородных тонкостенных и обильно ветвящихся гиф, то у трутовиков с копытообразными плодовыми телами они сложены гифами двух или трех типов: кроме тонкостенных, в них можно видеть толстостенные, малоразветвленные скелетные гифы и такие же толстостенные, но обильно ветвящиеся связывающие гифы, выполняющие механические функции. В плодовых телах млечников имеются специальные гифы, содержащие млечный сок, — млечные ходы.
Пожалуй, наиболее распространенный тип плодового тела у гименомицетов — это шляпочный гриб, т. е. плодовое тело, состоящее из шляпки на ножке. Плодовые тела этого типа обычно имеют мягкомясистую консистенцию и быстро загнивают, реже они бывают восковатой или кожистой консистенции. У негниючников они не загнивают, о чем говорит само их название, а высыхают в сухую погоду, вновь оживая после дождя. У навозников плодовое тело в зрелом возрасте расплывается (автолизируется). Шляпка и ножка могут быть самой разнообразной формы, причем их форма всегда постоянна и характерна для того или иного вида. Шляпка покрыта сверху кожицей, окраска и характер которой разнообразны. Окраска ее обычно определяет окраску шляпки, а кожица может быть гладкой, бархатистой, чешуйчатой и т. д., сухой или слизистой — она защищает мякоть шляпки от высыхания и повреждений. Мякоть шляпки может иметь различную консистенцию от плотной до рыхлой и губчатой, окраска ее обычно светлая, белая, желтоватая, светло-охряная или буроватая, однако на разломе или разрезе у некоторых грибов. например синяка, подосиновика, поддубника и др., ее окраска меняется: мякоть синеет, краснеет и темнеет. В мякоти млечников — рыжиков, груздей и др. — содержится бесцветный, белый или яркоокрашенный млечный сок, который на воздухе может изменять окраску.
 Пример геопропизма у трутовиков. Плодовые тела всегда расположены на стволах деревьев так, что их трубочки направлены строго вертикально к поверхности земли
На нижней стороне шляпки расположен гименофор в виде пластинок или трубочек, очень редко в виде шипиков (у ежевика желтого) или складок (у лисичек). Пластинки по-разному прикрепляются к ножке: могут быть свободными, не сросшимися с ножкой, иногда они прикрепляются к ней на разном протяжении и бывают от низбегающих по ножке до выемчатых. Окраска пластинок и трубочек тоже разнообразна — от белой до темной, даже черной и обычно зависит от окраски базидиоспор, порошок которых может быть белым, желтоватым, розовым, охряным, оливковым, коричневым, фиолетово-бурым, пурпурно-бурым и черным.
Пример геопропизма у трутовиков. Плодовые тела всегда расположены на стволах деревьев так, что их трубочки направлены строго вертикально к поверхности земли
На нижней стороне шляпки расположен гименофор в виде пластинок или трубочек, очень редко в виде шипиков (у ежевика желтого) или складок (у лисичек). Пластинки по-разному прикрепляются к ножке: могут быть свободными, не сросшимися с ножкой, иногда они прикрепляются к ней на разном протяжении и бывают от низбегающих по ножке до выемчатых. Окраска пластинок и трубочек тоже разнообразна — от белой до темной, даже черной и обычно зависит от окраски базидиоспор, порошок которых может быть белым, желтоватым, розовым, охряным, оливковым, коричневым, фиолетово-бурым, пурпурно-бурым и черным.
 После падения ствола дерева на старом плодовом теле под углом к нему выросло новое
Молодое плодовое тело часто окружено мицелиальным сплетением — общим покрывалом. По мере роста покрывало разрывается, а его остатки сохраняются у основания ножки в виде мешковидной или приросшей вольвы, а на шляпке — в виде разбросанных по ее поверхности лоскутов или хлопьев, например у мухомора. Иногда образуется покрывало другого типа, соединяющее край шляпки с верхней частью ножки и прикрывающее развивающийся гименофор, — его называют частным. Такое покрывало образуется у мухоморов, шампиньонов, некоторых маслят и других грибов и после разрыва сохраняется на ножке в виде кольца. У некоторых видов оно волокнистое или паутинистое (у паутинников), а также может быть слизистым (у мокрухи).
Гастеромицеты, как и гименомицеты, часто образуют очень большое количество базидиоспор. У дождевиков, например, их число достигает 7 биллионов, а в огромных плодовых телах лангермании гигантской их более 100 триллионов. У гастеромицетов не происходит активного отбрасывания базидиоспор от базидий, они освобождаются еще внутри оболочки плодового тела в результате разрушения базидий. Оболочка плодового тела (перидий) у гастеромицетов обычно хорошо развита и может состоять из одного или нескольких слоев. Ее разрушение и освобождение базидиоспор происходят разными способами.
После падения ствола дерева на старом плодовом теле под углом к нему выросло новое
Молодое плодовое тело часто окружено мицелиальным сплетением — общим покрывалом. По мере роста покрывало разрывается, а его остатки сохраняются у основания ножки в виде мешковидной или приросшей вольвы, а на шляпке — в виде разбросанных по ее поверхности лоскутов или хлопьев, например у мухомора. Иногда образуется покрывало другого типа, соединяющее край шляпки с верхней частью ножки и прикрывающее развивающийся гименофор, — его называют частным. Такое покрывало образуется у мухоморов, шампиньонов, некоторых маслят и других грибов и после разрыва сохраняется на ножке в виде кольца. У некоторых видов оно волокнистое или паутинистое (у паутинников), а также может быть слизистым (у мокрухи).
Гастеромицеты, как и гименомицеты, часто образуют очень большое количество базидиоспор. У дождевиков, например, их число достигает 7 биллионов, а в огромных плодовых телах лангермании гигантской их более 100 триллионов. У гастеромицетов не происходит активного отбрасывания базидиоспор от базидий, они освобождаются еще внутри оболочки плодового тела в результате разрушения базидий. Оболочка плодового тела (перидий) у гастеромицетов обычно хорошо развита и может состоять из одного или нескольких слоев. Ее разрушение и освобождение базидиоспор происходят разными способами.
 Типы расположения пластинок по отношению к ножке у шляпочных грибов: 1 — свободные; 2, 3 — приросшие; 4 — приросшие зубцом; 5 — нисходящие; 6 — приросшие к выросту ножки — коллариуму.
Как и у гименомицетов, у гастеромицетов эволюция шла по пути повышения эффективного рассеивания спор. У дождевиков и порховок плодовые тела вскрываются относительно небольшим отверстием на вершине, через которое при малейшем сотрясении, ударах капель дождя или порывах ветра вылетают базидиоспоры. Высыпание спор у этих грибов облегчается тем, что в их плодовых телах, в споровой массе, находятся нити капиллиция, при гигроскопических движениях которого масса разрыхляется. У головачей, или кальваций, перидий в верхней части плодового тела полностью разрушается, и оно приобретает форму, чаши. У близкой к ним лангермании гигантской перидий при созревании плодового тела растрескивается и отваливается неправильными кусками, обнажая споры. У звездовиков, называемых также земляными звездочками, наружный перидий состоит из трех слоев. Разрываясь на несколько остроконечных лопастей, он отгибается вниз в виде звездочки, за что эти грибы и получили свое название. У некоторых звездовиков он при этом еще и расслаивается, причем внутренний его слой выворачивается, поднимая плодовое тело, одетое внутренним перидием, над поверхностью почвы, как на ножках.
Типы расположения пластинок по отношению к ножке у шляпочных грибов: 1 — свободные; 2, 3 — приросшие; 4 — приросшие зубцом; 5 — нисходящие; 6 — приросшие к выросту ножки — коллариуму.
Как и у гименомицетов, у гастеромицетов эволюция шла по пути повышения эффективного рассеивания спор. У дождевиков и порховок плодовые тела вскрываются относительно небольшим отверстием на вершине, через которое при малейшем сотрясении, ударах капель дождя или порывах ветра вылетают базидиоспоры. Высыпание спор у этих грибов облегчается тем, что в их плодовых телах, в споровой массе, находятся нити капиллиция, при гигроскопических движениях которого масса разрыхляется. У головачей, или кальваций, перидий в верхней части плодового тела полностью разрушается, и оно приобретает форму, чаши. У близкой к ним лангермании гигантской перидий при созревании плодового тела растрескивается и отваливается неправильными кусками, обнажая споры. У звездовиков, называемых также земляными звездочками, наружный перидий состоит из трех слоев. Разрываясь на несколько остроконечных лопастей, он отгибается вниз в виде звездочки, за что эти грибы и получили свое название. У некоторых звездовиков он при этом еще и расслаивается, причем внутренний его слой выворачивается, поднимая плодовое тело, одетое внутренним перидием, над поверхностью почвы, как на ножках.
 Схема строения плодового тела на разных стадиях развития: 1 — общее покрывало или его остатки в виде чешуек на шляпке; 2 — пластинки; 3 — частное покрывало и его остатки в виде кольца на ножке; 4 — ножка; 5 — вольва — остаток общего покрывала
Среди гастеромицетов есть и такие, у которых внутренняя часть плодового тела со спорами (глеба) может активно отбрасываться на большое расстояние — до нескольких метров. У сфероболюса звездчатого, маленькие, около 1-2 мм диаметром, шаровидные плодовые тела которого часто можно встретить на гниющей древесине, перидий многослойный, причем слои имеют разное строение. После созревания базидиоспор он разрывается от вершины к основанию звездообразно на 6-8 лопастей, расслаивается и внутренний слой быстро выворачивается наизнанку, отбрасывая глебу. У близких к сфероболюсу гнездовки и круцибулюма, или бокальчика, также обитающих на гнилой древесине, плодовые тела имеют вид крошечных чашечек или бокальчиков размером не более 1 -1,5 см, в которых лежат, как яйца в гнезде, округлые уплощенные перидиоли, содержащие внутри базидиоспоры и прикрепленные спирально закрученным канатиком к стенке чашечки. Если капля дождя упадет в такую чашечку, она разбрызгивается и выбрасывает из чашечки перидиолю. Канатик служит для прикрепления выброшенной перидиоли к субстрату — растениям, их остаткам и т. п.
Схема строения плодового тела на разных стадиях развития: 1 — общее покрывало или его остатки в виде чешуек на шляпке; 2 — пластинки; 3 — частное покрывало и его остатки в виде кольца на ножке; 4 — ножка; 5 — вольва — остаток общего покрывала
Среди гастеромицетов есть и такие, у которых внутренняя часть плодового тела со спорами (глеба) может активно отбрасываться на большое расстояние — до нескольких метров. У сфероболюса звездчатого, маленькие, около 1-2 мм диаметром, шаровидные плодовые тела которого часто можно встретить на гниющей древесине, перидий многослойный, причем слои имеют разное строение. После созревания базидиоспор он разрывается от вершины к основанию звездообразно на 6-8 лопастей, расслаивается и внутренний слой быстро выворачивается наизнанку, отбрасывая глебу. У близких к сфероболюсу гнездовки и круцибулюма, или бокальчика, также обитающих на гнилой древесине, плодовые тела имеют вид крошечных чашечек или бокальчиков размером не более 1 -1,5 см, в которых лежат, как яйца в гнезде, округлые уплощенные перидиоли, содержащие внутри базидиоспоры и прикрепленные спирально закрученным канатиком к стенке чашечки. Если капля дождя упадет в такую чашечку, она разбрызгивается и выбрасывает из чашечки перидиолю. Канатик служит для прикрепления выброшенной перидиоли к субстрату — растениям, их остаткам и т. п.
 Молодые дождевики
Молодые дождевики
 Зрелые дождевики
Большая группа гастеромицетов — фаллюсовые — адаптировалась к распространению базидиоспор при помощи насекомых. Глеба у них после созревания расплывается в слизь, содержащую базидиоспоры. Слизь имеет очень сильный запах падали, привлекающий мух и других насекомых, которые и переносят базидиоспоры. У часто встречающейся у нас в лесах веселки обыкновенной темно-зеленая слизистая глеба располагается, как шляпка, на длинной губчатой ножке — рецептакуле. У тропических грибов — решеточника и цветохвостника — рецептакул более сложного строения: у первого он имеет вид сетчатого яйцевидного образования, внутри которого располагается слизистая глеба, а у второго рецептакул состоит из короткой ножки, от которой отходят длинные лопасти, соединенные на вершине или звездчато отгибающиеся. Рецептакул у этих грибов ярко окрашен, что также привлекает к ним насекомых.
Зрелые дождевики
Большая группа гастеромицетов — фаллюсовые — адаптировалась к распространению базидиоспор при помощи насекомых. Глеба у них после созревания расплывается в слизь, содержащую базидиоспоры. Слизь имеет очень сильный запах падали, привлекающий мух и других насекомых, которые и переносят базидиоспоры. У часто встречающейся у нас в лесах веселки обыкновенной темно-зеленая слизистая глеба располагается, как шляпка, на длинной губчатой ножке — рецептакуле. У тропических грибов — решеточника и цветохвостника — рецептакул более сложного строения: у первого он имеет вид сетчатого яйцевидного образования, внутри которого располагается слизистая глеба, а у второго рецептакул состоит из короткой ножки, от которой отходят длинные лопасти, соединенные на вершине или звездчато отгибающиеся. Рецептакул у этих грибов ярко окрашен, что также привлекает к ним насекомых.
 Звездовики, которых называют ещё земляными звездочками за необычную для грибов форму
Звездовики, которых называют ещё земляными звездочками за необычную для грибов форму
Приспособления к распространению
Споры грибов можно обнаружить везде — в почве, воде, воздухе и т. д. По воздуху они могут переноситься на большие расстояния. Так, споры возбудителя стеблевой ржавчины злаков могут подниматься токами воздуха на высоту более 2 км и переноситься на расстояние до нескольких тысяч километров. Они легко преодолевают пространства между Канадой и Техасом. Ржавчина кофейного дерева, впервые обнаруженная на Цейлоне в конце прошлого века, с 70-х годов текущего столетия появилась в Бразилии и поставила под угрозу производство кофе в основном районе его возделывания — в Центральной и Южной Америке. Оказалось, что споры паразита были занесены на Американский континент воздушными течениями из Западной Африки через Атлантический океан. На большие расстояния переносятся споры и других ржавчинных грибов, и это постоянно создает опасность эпифитотий ржавчины. Поэтому сейчас во всем мире созданы специальные службы прогноза, которые при помощи споровых ловушек определяют присутствие в воздухе спор ржавчинных грибов, пути их переноса и на этой основе предсказывают появление ржавчины в тех или иных районах. В воздухе в массе присутствуют также конидии многих микромицетов (кладоспориумов, альтернаний, пенициллов и др.) и базидиоспоры макромицетов. Сфероболюс и схема механизма отбрасывания перидиоли со спорами
В лесах большую роль в распространении базидиоспор макромицетов играют конвекционные токи воздуха, возникающие из-за неравномерного нагревания его в кронах деревьев и у поверхности почвы. Споры грибов захватываются восходящими токами воздуха и на большой высоте подхватываются ветром, который может перенести их на значительные расстояния. Вероятность попадания спор на подходящий для их прорастания субстрат при этом невелика, большинство из них погибает, однако у грибов с таким способом переноса спор они образуются в очень больших количествах.
Споры водных грибов (зооспоры первично водных грибов, а также конидии и аскоспоры грибов, перешедших к жизни в водной среде вторично, с суши) переносятся на большие расстояния токами воды. У головневых грибов доассансии и доассансиопсиса — паразитов стрелолиста, рдеста и других водных и болотных растений — головневые споры собраны в шаровидные клубочки, в которых содержатся многочисленные стерильные клетки, что значительно увеличивает отношение их объема к массе и повышает плавучесть. Спорынья, поражающая водный злак глицерию, образует очень рыхлые склероции, содержащие в тканях много воздуха, поэтому очень легкие и хорошо переносящиеся водой.
Сфероболюс и схема механизма отбрасывания перидиоли со спорами
В лесах большую роль в распространении базидиоспор макромицетов играют конвекционные токи воздуха, возникающие из-за неравномерного нагревания его в кронах деревьев и у поверхности почвы. Споры грибов захватываются восходящими токами воздуха и на большой высоте подхватываются ветром, который может перенести их на значительные расстояния. Вероятность попадания спор на подходящий для их прорастания субстрат при этом невелика, большинство из них погибает, однако у грибов с таким способом переноса спор они образуются в очень больших количествах.
Споры водных грибов (зооспоры первично водных грибов, а также конидии и аскоспоры грибов, перешедших к жизни в водной среде вторично, с суши) переносятся на большие расстояния токами воды. У головневых грибов доассансии и доассансиопсиса — паразитов стрелолиста, рдеста и других водных и болотных растений — головневые споры собраны в шаровидные клубочки, в которых содержатся многочисленные стерильные клетки, что значительно увеличивает отношение их объема к массе и повышает плавучесть. Спорынья, поражающая водный злак глицерию, образует очень рыхлые склероции, содержащие в тканях много воздуха, поэтому очень легкие и хорошо переносящиеся водой.
 Циатус, или бокальчик (схема отбрасывания перидиоли)
Вода участвует и в распространении спор многих наземных грибов. Мы уже упоминали о том, что перидиоли гнездовок и бокальчиков выбрасываются из плодовых тел под ударами капель дождя. Очень эффективно распространяются дождем и конидии нектрии киноварно-красной, часто образующей оранжево-розовые подушечки диаметром до 2 мм на отмерших ветвях деревьев и кустарников, а иногда и на живых деревьях. Крупная дождевая капля, диаметром около 5 мм, падая с высоты на ветку с такими конидиальными подушечками, разбрызгивается на несколько тысяч мельчайших капелек, каждая из которых содержит конидии гриба.
Споры многих грибов распространяются и различными животными. У грибов с крупными подземными плодовыми телами споры обычно переносятся позвоночными, которые находят такие грибы по запаху и поедают их; обычно такие плодовые тела имеют очень характерный острый запах. Олени и кабаны часто питаются плодовыми телами элафомицесов, которые поэтому даже называют в ряде стран Европы и Америки оленьими трюфелями. Споры настоящих трюфелей также часто распространяются животными, которые легко находят эти грибы по запаху. На этом даже основан старый способ массового сбора трюфелей при помощи дрессированных животных — собак или свиней, известный в Италии с XV в. и до сих пор распространенный в некоторых районах Франции. Свинья, например, может обнаружить трюфель по запаху на расстоянии до 20 м. Споры шляпочных грибов распространяются белками и бурундуками, а настоящий домовый гриб, вызывающий сильные разрушения деревянных конструкций в постройках, нередко переносится мышами.
Активно участвуют в распространении спор грибов птицы. Известны случаи, когда они переносили возбудителя опасного заболевания сеянцов сосны — шютте, а также многих других болезней растений.
Своеобразные приспособления к распространению спор приобрели многочисленные копрофильные грибы, т. е. грибы, обитающие на экскрементах животных, преимущественно травоядных, — пилоболус, сордария, аскоболус, саккоболус и др. Для эффективного переноса спор этих грибов необходимо, чтобы они попали с пищей в пищеварительный тракт животного, а затем с навоза на траву. Поэтому у всех грибов из названной группы возникли приспособления, повышающие вероятность попадания их спор на растения: активное выбрасывание спор на такие расстояния, что они могут попасть на траву без участия ветра; фототропические реакции органов спороношения, направляющие выбрасываемые споры в сторону источника света; образование на спорах слизистой обертки или придатков, при помощи которых они приклеиваются к траве.
Циатус, или бокальчик (схема отбрасывания перидиоли)
Вода участвует и в распространении спор многих наземных грибов. Мы уже упоминали о том, что перидиоли гнездовок и бокальчиков выбрасываются из плодовых тел под ударами капель дождя. Очень эффективно распространяются дождем и конидии нектрии киноварно-красной, часто образующей оранжево-розовые подушечки диаметром до 2 мм на отмерших ветвях деревьев и кустарников, а иногда и на живых деревьях. Крупная дождевая капля, диаметром около 5 мм, падая с высоты на ветку с такими конидиальными подушечками, разбрызгивается на несколько тысяч мельчайших капелек, каждая из которых содержит конидии гриба.
Споры многих грибов распространяются и различными животными. У грибов с крупными подземными плодовыми телами споры обычно переносятся позвоночными, которые находят такие грибы по запаху и поедают их; обычно такие плодовые тела имеют очень характерный острый запах. Олени и кабаны часто питаются плодовыми телами элафомицесов, которые поэтому даже называют в ряде стран Европы и Америки оленьими трюфелями. Споры настоящих трюфелей также часто распространяются животными, которые легко находят эти грибы по запаху. На этом даже основан старый способ массового сбора трюфелей при помощи дрессированных животных — собак или свиней, известный в Италии с XV в. и до сих пор распространенный в некоторых районах Франции. Свинья, например, может обнаружить трюфель по запаху на расстоянии до 20 м. Споры шляпочных грибов распространяются белками и бурундуками, а настоящий домовый гриб, вызывающий сильные разрушения деревянных конструкций в постройках, нередко переносится мышами.
Активно участвуют в распространении спор грибов птицы. Известны случаи, когда они переносили возбудителя опасного заболевания сеянцов сосны — шютте, а также многих других болезней растений.
Своеобразные приспособления к распространению спор приобрели многочисленные копрофильные грибы, т. е. грибы, обитающие на экскрементах животных, преимущественно травоядных, — пилоболус, сордария, аскоболус, саккоболус и др. Для эффективного переноса спор этих грибов необходимо, чтобы они попали с пищей в пищеварительный тракт животного, а затем с навоза на траву. Поэтому у всех грибов из названной группы возникли приспособления, повышающие вероятность попадания их спор на растения: активное выбрасывание спор на такие расстояния, что они могут попасть на траву без участия ветра; фототропические реакции органов спороношения, направляющие выбрасываемые споры в сторону источника света; образование на спорах слизистой обертки или придатков, при помощи которых они приклеиваются к траве.
 Фаллюс (веселка) на разных стадиях развития. Рисунок из 'Кодекса Клузиуса'
Пилоболус, относящийся к мукоровым грибам, образует на навозе множество спорангиев. Спорангиеносец у него в верхней части, под сплющенным черным спорангием, расширяется в большой пузырь — подспорангиальное вздутие. Оно играет большую роль в фототропическом изгибе спорангиеносца и наводке спорангия в сторону источника света. При одностороннем освещении лучи света преломляются в этом вздутии и у его основания на противоположной стороне образуется световое пятно. В этой зоне происходит интенсивный рост, приводящий в результате к изгибу спорангиеносца в сторону источника света. В результате повышения тургорного давления в спорангиеносце оболочка вздутия внезапно лопается, и спорангий отбрасывается на расстояние до 2 м. Отброшенные в сторону источника света спорангии прилипают к траве и попадают с ней в пищеварительный тракт животного.
Фаллюс (веселка) на разных стадиях развития. Рисунок из 'Кодекса Клузиуса'
Пилоболус, относящийся к мукоровым грибам, образует на навозе множество спорангиев. Спорангиеносец у него в верхней части, под сплющенным черным спорангием, расширяется в большой пузырь — подспорангиальное вздутие. Оно играет большую роль в фототропическом изгибе спорангиеносца и наводке спорангия в сторону источника света. При одностороннем освещении лучи света преломляются в этом вздутии и у его основания на противоположной стороне образуется световое пятно. В этой зоне происходит интенсивный рост, приводящий в результате к изгибу спорангиеносца в сторону источника света. В результате повышения тургорного давления в спорангиеносце оболочка вздутия внезапно лопается, и спорангий отбрасывается на расстояние до 2 м. Отброшенные в сторону источника света спорангии прилипают к траве и попадают с ней в пищеварительный тракт животного.
 Нектрия
Все указанные выше приспособления можно наблюдать и у копрофильных дискомицетов, например аскоболуса. Его споры крупные (до 50-70 мкм) и выбрасываются обычно на расстояние до 25-60 см. Сумки у зрелого гриба выступают над поверхностью гимения, они положительно фототропичны и выбрасывают аскоспоры в направлении источника света. Аскоспоры окружены слизью и легко прилипают к траве.
Очень многие грибы распространяются насекомыми. Часто споры этих грибов имеют слизистую обертку или погружены в слизь, нередко имеющую резкий неприятных запах, привлекающий насекомых. Насекомые способны переносить и споры многих паразитов растений. Так, возбудитель голландской болезни вяза — цератоцистис вязовый — распространяется жуками-короедами. Весной на больных вязах развивается конидиальное спороношение этого гриба со спорами, погруженными в слизь. Это совпадает по времени с весенним лётом ильмовых заболонников — основных переносчиков возбудителя Жуки заносят споры гриба в свои ходы, вызывая заражение новых деревьев. Перитеции гриба образуются на коре больных деревьев и в ходах короедов. Аскоспоры, как и конидии, погружены в слизь, и это облегчает их перенос насекомыми.
Мухи и другие насекомые переносят и конидии спорыньи. При массовом развитии конидий этого гриба образуется так называемая медвяная роса — капли жидкости с неприятным запахом и высоким содержанием Сахаров, в которые и погружены конидии. В этот период вокруг пораженных спорыньей колосьев кружится множество насекомых, переносящих медвяную росу с конидиями паразита на здоровые растения. Однако конидии спорыньи могут распространяться не только насекомыми, но и каплями дождя, при трении колосьев друг о друга под действием ветра, а после высыхания медвяной росы — ветром.
Споры шляпочных грибов, вероятно, могут переноситься муравьями. Вокруг муравейников часто можно обнаружить лесные шампиньоны, грибы-зонтики и земляные звездочки. Некоторые виды муравьев из рода атта, обитающие в Южной Америке, разводят в муравейниках целые грибные сады, подготавливая для этого специальный субстрат из пережеванных листьев и "засевая" его грибницей определенных видов грибов. Мицелий, выращенный в грибных садах, эти муравьи используют в пищу. Подобные же грибные сады устраивают и многие виды термитов, выращивая грибы на измельченной древесине.
В мякоти шляпочных грибов часто можно обнаружить личинок грибных мух и комариков (грибы, как говорят, червивеют). Личинки и взрослые особи этих насекомых, питаясь мякотью или откладывая яички, переносят таким образом споры грибов.
Нередко и человек в процессе своей деятельности распространяет грибы. Многие паразиты растений были перевезены с одних континентов на другие. Из Америки в Европу в 1842-1843 гг. была завезена фитофтора — возбудитель картофельной болезни, причинившая огромный ущерб во многих странах. Из Европы в Америку в 1930-1933 гг. через порты Атлантики и Мексиканского залива с вязовыми бревнами, пораженными короедами, был завезен возбудитель голландской болезни вязов, вызвавшей массовую гибель ильмовых в некоторых штатах.
Часто возбудители болезней могут быть завезены из одной страны в другую с посадочным материалом, семенами, растениями. Поэтому во многих странах создана специальная карантинная служба, в задачи которой входит проверка привозимого материала и предотвращение завоза возбудителей.
С зараженным материалом и орудиями обработки почвы распространяются и многие болезни в пределах одной страны или района. Так, склероции спорыньи часто попадали в поле с недостаточно очищенным зерном. Головневые грибы переносятся как в виде головневых спор на поверхности семян их хозяев (например, твердая головня пшеницы), так и внутри их в виде мицелия, поражающего зародыш (пыльная головня пшеницы и ячменя). Для борьбы с такими паразитами разработаны специальные меры — протравливание семян фунгицидами и термическая обработка.
Нектрия
Все указанные выше приспособления можно наблюдать и у копрофильных дискомицетов, например аскоболуса. Его споры крупные (до 50-70 мкм) и выбрасываются обычно на расстояние до 25-60 см. Сумки у зрелого гриба выступают над поверхностью гимения, они положительно фототропичны и выбрасывают аскоспоры в направлении источника света. Аскоспоры окружены слизью и легко прилипают к траве.
Очень многие грибы распространяются насекомыми. Часто споры этих грибов имеют слизистую обертку или погружены в слизь, нередко имеющую резкий неприятных запах, привлекающий насекомых. Насекомые способны переносить и споры многих паразитов растений. Так, возбудитель голландской болезни вяза — цератоцистис вязовый — распространяется жуками-короедами. Весной на больных вязах развивается конидиальное спороношение этого гриба со спорами, погруженными в слизь. Это совпадает по времени с весенним лётом ильмовых заболонников — основных переносчиков возбудителя Жуки заносят споры гриба в свои ходы, вызывая заражение новых деревьев. Перитеции гриба образуются на коре больных деревьев и в ходах короедов. Аскоспоры, как и конидии, погружены в слизь, и это облегчает их перенос насекомыми.
Мухи и другие насекомые переносят и конидии спорыньи. При массовом развитии конидий этого гриба образуется так называемая медвяная роса — капли жидкости с неприятным запахом и высоким содержанием Сахаров, в которые и погружены конидии. В этот период вокруг пораженных спорыньей колосьев кружится множество насекомых, переносящих медвяную росу с конидиями паразита на здоровые растения. Однако конидии спорыньи могут распространяться не только насекомыми, но и каплями дождя, при трении колосьев друг о друга под действием ветра, а после высыхания медвяной росы — ветром.
Споры шляпочных грибов, вероятно, могут переноситься муравьями. Вокруг муравейников часто можно обнаружить лесные шампиньоны, грибы-зонтики и земляные звездочки. Некоторые виды муравьев из рода атта, обитающие в Южной Америке, разводят в муравейниках целые грибные сады, подготавливая для этого специальный субстрат из пережеванных листьев и "засевая" его грибницей определенных видов грибов. Мицелий, выращенный в грибных садах, эти муравьи используют в пищу. Подобные же грибные сады устраивают и многие виды термитов, выращивая грибы на измельченной древесине.
В мякоти шляпочных грибов часто можно обнаружить личинок грибных мух и комариков (грибы, как говорят, червивеют). Личинки и взрослые особи этих насекомых, питаясь мякотью или откладывая яички, переносят таким образом споры грибов.
Нередко и человек в процессе своей деятельности распространяет грибы. Многие паразиты растений были перевезены с одних континентов на другие. Из Америки в Европу в 1842-1843 гг. была завезена фитофтора — возбудитель картофельной болезни, причинившая огромный ущерб во многих странах. Из Европы в Америку в 1930-1933 гг. через порты Атлантики и Мексиканского залива с вязовыми бревнами, пораженными короедами, был завезен возбудитель голландской болезни вязов, вызвавшей массовую гибель ильмовых в некоторых штатах.
Часто возбудители болезней могут быть завезены из одной страны в другую с посадочным материалом, семенами, растениями. Поэтому во многих странах создана специальная карантинная служба, в задачи которой входит проверка привозимого материала и предотвращение завоза возбудителей.
С зараженным материалом и орудиями обработки почвы распространяются и многие болезни в пределах одной страны или района. Так, склероции спорыньи часто попадали в поле с недостаточно очищенным зерном. Головневые грибы переносятся как в виде головневых спор на поверхности семян их хозяев (например, твердая головня пшеницы), так и внутри их в виде мицелия, поражающего зародыш (пыльная головня пшеницы и ячменя). Для борьбы с такими паразитами разработаны специальные меры — протравливание семян фунгицидами и термическая обработка.
 У грибов, растущих на муравейниках, как этот лесной шампиньон, споры могут переносить и муравьи
С почвой или посадочным материалом переносятся часто споры и мицелий макромицетов. С таким переносом связаны, в частности, многочисленные находки тропических и субтропических гастеромицетов в оранжереях, ботанических садах и парках, расположенных в районах с умеренным климатом.
У грибов, растущих на муравейниках, как этот лесной шампиньон, споры могут переносить и муравьи
С почвой или посадочным материалом переносятся часто споры и мицелий макромицетов. С таким переносом связаны, в частности, многочисленные находки тропических и субтропических гастеромицетов в оранжереях, ботанических садах и парках, расположенных в районах с умеренным климатом.
Особенности развития грибов
По мере роста грибов их облик неузнаваемо меняется. Сначала развивается паутинистый, пушистый или ватообразный, часто тяжистый мицелий, продолжительность жизни которого у одних грибов 1-2 недели, а у других многие годы. Затем на мицелии образуются органы спороношения, и вид гриба становится совсем иным. У многих микроскопических грибов это наступает очень быстро, через несколько дней. Это легко заметить, выращивая в культуре, например, пеницилл. Его колония, сначала белая и пушистая, через 4-5 дней, а часто и раньше меняет свою окраску на зеленую или голубую и становится порошистой от многочисленных спор. У грибов-паразитов растений, например, мучнисторосяных или ржавчинных, споры бесполого размножения тоже образуются уже через несколько дней после заражения растения. У макромицетов плодовые тела образуются часто 1 раз в год (например, у сморчков и строчков весной, у фиолетовой рядовки поздней осенью) или несколькими волнами в течение лета и осени (например, у белых грибов). Нередко при неблагоприятных условиях плодоношение не наступает, хотя мицелий сохраняет свою жизнеспособность. Все знают, что на хорошо известных грибникам местах не каждый год можно найти грибы. В своей книге, специально посвященной белому грибу, известный советский миколог Б. П. Васильков отмечает, что у этого гриба массовое плодоношение наступает через 2-4 года. У большинства макромицетов плодовые тела развиваются довольно быстро: у шляпочных грибов, например, от появления зачатка плодового тела до окончания роста проходит 10-15 дней, а созревание спор начинается уже на 5-7-й день. Сохраняется такое плодовое тело после созревания недолго — от нескольких часов у мелких навозников до нескольких дней. В отличие от шляпочных грибов трутовики часто образуют многолетние плодовые тела. Развитие их происходит очень медленно, прирост наблюдается только в теплые, влажные периоды, а в остальное время затормаживается. Поэтому на гименофоре этих плодовых тел часто заметна слоистость. Часто один и тот же гриб образует в цикле своего развития не одно, а несколько спороношений. Они чередуются, следуя одно за другим, и каждый раз гриб меняет форму. У некоторых грибов и ветегативное тело может видоизменяться на протяжении жизни, переходя в зависимости от условий внешней среды от мицелиального роста к дрожжеподобному и наоборот. Такие изменения формы грибов в течение жизни получили название полиморфизма. Полиморфизм, связанный со сменой дрожжевой и мицелиальной форм роста в ходе вегетативного развития гриба обычно называют диморфизмом, а со сменой разных типов спороношений — плеоморфизмом. Явление плеоморфизма грибов вызывает большие затруднения в работе микологов. Действительно, если не исследовать связи между отдельными спороношениями, каждое из них можно принять за самостоятельный гриб. Вспомним, что даже связь плодовых тел макромицетов с их мицелием удалось доказать только в 30-х годах XIX в., изучение же циклов развития у микромицетов намного сложнее и требует специальных методов выращивания грибов в чистой культуре, искусственного заражения растений и др. Микологи долго описывали бесполые и половые спороношения гриба как разные виды. Так были описаны сизый аспергилл и гербарный эуроциум, и только в 1854 г. известный немецкий миколог А. де Бари доказал, что это конидиальная и сумчатая стадии одного вида. Плодовое тело навозника недолговечно, от появления его зачатка до полного автолиза проходит всего несколько часов
Еще более яркие примеры плеоморфизма мы встречаем у грибов — паразитов растений. Здесь дело осложняется и тем, что обычно конидиальные и сумчатые спороношения аскомицетов-паразитов образуются в разных условиях: первые — на живом растении в период вегетации и служат для расселения гриба, а последние — в конце периода вегетации и осенью, часто уже на отмерших частях растения и служат для перезимовки гриба и первичного заражения растений весной. Многие, наверное, обращали внимание на темно-оливковые или оливково-черные бархатистые пятна на листьях и плодах яблонь и груш. Это — конидиальная стадия возбудителей так называемой парши этих растений. Сумчатая стадия этого гриба развивается на опавших листьях, а аскоспоры созревают только весной и заражают молодые листья после их распускания.
Сложный цикл развития и у другого паразитного сумчатого гриба — спорыньи, поражающей рожь и другие злаки, культурные и дикорастущие. В цикле выделяются три следующие друг за другом стадии. На пораженных грибом растениях в соцветиях вместо отдельных зерен образуются склероции, имеющие вид рожков черно-фиолетового цвета. При уборке урожая склероции попадают в почву и здесь зимуют, а весной прорастают несколькими стромами — красноватыми головками диаметром 1 -1,5 мм на длинных тонких ножках. В стромах образуются аскоспоры, которые созревают к моменту цветения злаков. После выбрасывания из перитециев аскоспоры разносятся ветром и, попав на цветок, прорастают — их мицелий проникает в завязь. Через несколько дней после заражения на растениях развивается конидиальная стадия. Конидии гриба, погруженные в медвяную росу, переносятся насекомыми на другие растения и заражают их. Уже через 1--2 недели после появления медвяной росы образуются первые склероции, но развиваются они медленно и созревают ко времени созревания зерна. Непохожие друг на друга склероции, головчатые стромы и конидиальное спороношение долгое время считали разными видами грибов, пока французский миколог Л. Р. Тюлянь в середине прошлого века не доказал их связь.
Плодовое тело навозника недолговечно, от появления его зачатка до полного автолиза проходит всего несколько часов
Еще более яркие примеры плеоморфизма мы встречаем у грибов — паразитов растений. Здесь дело осложняется и тем, что обычно конидиальные и сумчатые спороношения аскомицетов-паразитов образуются в разных условиях: первые — на живом растении в период вегетации и служат для расселения гриба, а последние — в конце периода вегетации и осенью, часто уже на отмерших частях растения и служат для перезимовки гриба и первичного заражения растений весной. Многие, наверное, обращали внимание на темно-оливковые или оливково-черные бархатистые пятна на листьях и плодах яблонь и груш. Это — конидиальная стадия возбудителей так называемой парши этих растений. Сумчатая стадия этого гриба развивается на опавших листьях, а аскоспоры созревают только весной и заражают молодые листья после их распускания.
Сложный цикл развития и у другого паразитного сумчатого гриба — спорыньи, поражающей рожь и другие злаки, культурные и дикорастущие. В цикле выделяются три следующие друг за другом стадии. На пораженных грибом растениях в соцветиях вместо отдельных зерен образуются склероции, имеющие вид рожков черно-фиолетового цвета. При уборке урожая склероции попадают в почву и здесь зимуют, а весной прорастают несколькими стромами — красноватыми головками диаметром 1 -1,5 мм на длинных тонких ножках. В стромах образуются аскоспоры, которые созревают к моменту цветения злаков. После выбрасывания из перитециев аскоспоры разносятся ветром и, попав на цветок, прорастают — их мицелий проникает в завязь. Через несколько дней после заражения на растениях развивается конидиальная стадия. Конидии гриба, погруженные в медвяную росу, переносятся насекомыми на другие растения и заражают их. Уже через 1--2 недели после появления медвяной росы образуются первые склероции, но развиваются они медленно и созревают ко времени созревания зерна. Непохожие друг на друга склероции, головчатые стромы и конидиальное спороношение долгое время считали разными видами грибов, пока французский миколог Л. Р. Тюлянь в середине прошлого века не доказал их связь.
 Стадии развития спорыньи
Часто в цикле развития гриба образуется не одно конидиальное спороношение, а несколько. Так происходит у паразита многих шляпочных грибов — апиокреи золотистоспоровой, которую легко можно найти с июля по сентябрь на моховиках, белых грибах, подосиновиках, подберезовиках и свинушках. Белый мицелий апиокреи пронизывает ткани плодового тела хозяина и его трубочки. В течение 3-5 дней на мицелии образуются мелкие неокрашенные тонкостенные споры, которые легко переносятся ветром или насекомыми и заражают другие грибы. Позднее, когда питание исчерпано, образуются золотисто-желтые крупные споры с утолщенной шиповатой оболочкой, заполняющие все плодовое тело и освобождающиеся после его разрушения. Эти споры более стойки к неблагоприятным условиям, чем споры первого типа, и могут сохранять жизнеспособность длительное время, иногда даже до весны следующего года. На уже разрушенных, гниющих плодовых телах образуются перитеции апиокреи, они зимуют, и аскоспоры в них созревают только весной. Поэтому в природе их находят очень редко.
Еще более сложный цикл развития у многих ржавчинных грибов. У пукцинии злаковой — возбудителя опасной болезни стеблевой ржавчины многих злаковых, вызывающей большие потери урожая при массовом ее развитии, в течение жизни сменяется пять различающихся по внешнему виду и функциям стадий развития. Этот гриб развивается не на одном растении-хозяине, а на двух, причем на каждом из них проходит строго определенные стадии жизненного цикла. Весной на листьях барбариса появляются оранжевые пятна. На верхней стороне листа на этих пятнах видны темные точки — это отверстия так называемых спермогониев, одного из спороношений гриба. На нижней поверхности листа на тех же пятнах образуются округлые или продолговатые чашечки — эцидии, в которых формируются шаровидные ярко-желтые или оранжевые споры — эцидиоспоры. Они заражают молодые растения злаков — основных хозяев гриба (пшеницу, рожь и др.), на стеблях и листьях которых развивается следующая стадия — яйцевидные, оранжевые с бесцветными ножками летние споры или уредоспоры; это спороношение хорошо заметно на пораженных ржавчиной растениях в виде ржаво-оранжевых подушечек или полосок.
Уредоспоры легко отламываются от ножек и переносятся ветром, заражая новые растения. В течение лета на злаках образуется несколько поколений уредоспор, поэтому при благоприятных для гриба условиях может происходить массовое поражение растений — эпифитотия. К концу лета летние споры сменяются зимними, или телейтоспорами, имеющими толстые темно-бурые оболочки. С их развитием вид пораженных растений меняется: стебли и влагалища листьев покрываются темно-бурыми или черными продолговатыми полосками. Телейтоспоры зимуют на стерне или стеблях дикорастущих злаков и там же прорастают весной, образуя четырехклеточную базидию с четырьмя бесцветными базидиоспорами, которые заражают листья барбариса. Таким образом, в цикле развития этого ржавчинного гриба происходит не только смена разных спороношений, но и смена растения-хозяина. Последнее явление называют разнохозяинностью. Оно встречается почти исключительно у ржавчинных грибов. Возбудитель пузырчатой ржавчины веймутовой и сибирской кедровой сосен образует на этих породах только эцидии, имеющие вид желтоватых выростов или пузырьков, а уредоспоры и телейтоспоры его развиваются на листьях смородины и крыжовника.
Возбудитель другого опасного заболевания сосны — ржавчины, или соснового вертуна, вызывающего искривления и нарушения роста молодых побегов, также образует на этом хозяине только эцидии, а его вторым хозяином является осина. Известны и однохозяинные ржавчинные грибы, например возбудитель ржавчины роз. В случаях разнохозяинности гриба очень трудно проследить полный цикл его развития и связать отдельные стадии развития воедино. Очень много работал в этом направлении советский миколог В. Г. Траншель, выяснивший такие связи у многочисленных ржавчинных грибов.
Стадии развития спорыньи
Часто в цикле развития гриба образуется не одно конидиальное спороношение, а несколько. Так происходит у паразита многих шляпочных грибов — апиокреи золотистоспоровой, которую легко можно найти с июля по сентябрь на моховиках, белых грибах, подосиновиках, подберезовиках и свинушках. Белый мицелий апиокреи пронизывает ткани плодового тела хозяина и его трубочки. В течение 3-5 дней на мицелии образуются мелкие неокрашенные тонкостенные споры, которые легко переносятся ветром или насекомыми и заражают другие грибы. Позднее, когда питание исчерпано, образуются золотисто-желтые крупные споры с утолщенной шиповатой оболочкой, заполняющие все плодовое тело и освобождающиеся после его разрушения. Эти споры более стойки к неблагоприятным условиям, чем споры первого типа, и могут сохранять жизнеспособность длительное время, иногда даже до весны следующего года. На уже разрушенных, гниющих плодовых телах образуются перитеции апиокреи, они зимуют, и аскоспоры в них созревают только весной. Поэтому в природе их находят очень редко.
Еще более сложный цикл развития у многих ржавчинных грибов. У пукцинии злаковой — возбудителя опасной болезни стеблевой ржавчины многих злаковых, вызывающей большие потери урожая при массовом ее развитии, в течение жизни сменяется пять различающихся по внешнему виду и функциям стадий развития. Этот гриб развивается не на одном растении-хозяине, а на двух, причем на каждом из них проходит строго определенные стадии жизненного цикла. Весной на листьях барбариса появляются оранжевые пятна. На верхней стороне листа на этих пятнах видны темные точки — это отверстия так называемых спермогониев, одного из спороношений гриба. На нижней поверхности листа на тех же пятнах образуются округлые или продолговатые чашечки — эцидии, в которых формируются шаровидные ярко-желтые или оранжевые споры — эцидиоспоры. Они заражают молодые растения злаков — основных хозяев гриба (пшеницу, рожь и др.), на стеблях и листьях которых развивается следующая стадия — яйцевидные, оранжевые с бесцветными ножками летние споры или уредоспоры; это спороношение хорошо заметно на пораженных ржавчиной растениях в виде ржаво-оранжевых подушечек или полосок.
Уредоспоры легко отламываются от ножек и переносятся ветром, заражая новые растения. В течение лета на злаках образуется несколько поколений уредоспор, поэтому при благоприятных для гриба условиях может происходить массовое поражение растений — эпифитотия. К концу лета летние споры сменяются зимними, или телейтоспорами, имеющими толстые темно-бурые оболочки. С их развитием вид пораженных растений меняется: стебли и влагалища листьев покрываются темно-бурыми или черными продолговатыми полосками. Телейтоспоры зимуют на стерне или стеблях дикорастущих злаков и там же прорастают весной, образуя четырехклеточную базидию с четырьмя бесцветными базидиоспорами, которые заражают листья барбариса. Таким образом, в цикле развития этого ржавчинного гриба происходит не только смена разных спороношений, но и смена растения-хозяина. Последнее явление называют разнохозяинностью. Оно встречается почти исключительно у ржавчинных грибов. Возбудитель пузырчатой ржавчины веймутовой и сибирской кедровой сосен образует на этих породах только эцидии, имеющие вид желтоватых выростов или пузырьков, а уредоспоры и телейтоспоры его развиваются на листьях смородины и крыжовника.
Возбудитель другого опасного заболевания сосны — ржавчины, или соснового вертуна, вызывающего искривления и нарушения роста молодых побегов, также образует на этом хозяине только эцидии, а его вторым хозяином является осина. Известны и однохозяинные ржавчинные грибы, например возбудитель ржавчины роз. В случаях разнохозяинности гриба очень трудно проследить полный цикл его развития и связать отдельные стадии развития воедино. Очень много работал в этом направлении советский миколог В. Г. Траншель, выяснивший такие связи у многочисленных ржавчинных грибов.
 Различные типы спор ржавчинного гриба
С явлением диморфизма у грибов мы встречаемся значительно реже, чем с плеоморфизмом. Некоторые грибы, развивающиеся в организме животных или человека, например возбудитель гистоплазмоза, образуют там дрожжевую фазу. Дрожжеподобный рост наблюдается у этого гриба и на специальных средах, в состав которых входит кровь, при повышенной температуре, а на обычных питательных средах для грибов при температуре 24°С и в почве он образует нормальный мицелий. У возбудителя голландской болезни вязов — цератоцистиса вязового — в сосудистой системе больного растения также развиваются многочисленные почкующиеся клетки, а на поверхности древесины, в ходах жуков-короедов и в культуре — мицелий. У некоторых мукоров в условиях недостатка кислорода, избытка углекислоты и присутствия высоких концентраций Сахаров также происходит распад мицелия на почкующиеся клетки.
Все многочисленные проявления полиморфизма у грибов — это тоже приспособления, позволяющие грибам существовать и эффективно размножаться в постоянно меняющихся условиях среды.
Различные типы спор ржавчинного гриба
С явлением диморфизма у грибов мы встречаемся значительно реже, чем с плеоморфизмом. Некоторые грибы, развивающиеся в организме животных или человека, например возбудитель гистоплазмоза, образуют там дрожжевую фазу. Дрожжеподобный рост наблюдается у этого гриба и на специальных средах, в состав которых входит кровь, при повышенной температуре, а на обычных питательных средах для грибов при температуре 24°С и в почве он образует нормальный мицелий. У возбудителя голландской болезни вязов — цератоцистиса вязового — в сосудистой системе больного растения также развиваются многочисленные почкующиеся клетки, а на поверхности древесины, в ходах жуков-короедов и в культуре — мицелий. У некоторых мукоров в условиях недостатка кислорода, избытка углекислоты и присутствия высоких концентраций Сахаров также происходит распад мицелия на почкующиеся клетки.
Все многочисленные проявления полиморфизма у грибов — это тоже приспособления, позволяющие грибам существовать и эффективно размножаться в постоянно меняющихся условиях среды.
Способы питания грибов. Грибы-сапротрофы и грибы-паразиты
Жизнь грибов в природе проходит под воздействием многочисленных факторов внешней среды, особенно разнообразных на суше, где обитает большинство ныне существующих видов грибов. Это химический состав субстрата, температура и влажность воздуха, содержание в нем кислорода и углекислоты, атмосферные осадки, интенсивность солнечной радиации, скорость ветра, взаимодействие с другими организмами — животными, растениями, микроорганизмами, наконец, различные антропогенные воздействия — вытаптывание, сбор грибов, выпас скота и др. Как уже упоминалось, по характеру питания грибы — гетеротрофы. В отличие от зеленых растений-автотрофов, содержащих хлорофилл, они не способны синтезировать сложные органические вещества из углерода углекислого газа воздуха, используя солнечную энергию, и вынуждены использовать готовые. Поэтому необходимое условие развития гриба — присутствие подходящего субстрата, из которого мицелий мог бы поглощать питательные вещества. В природе грибы находят его или в виде разнообразных органических остатков растительного и животного происхождения, на которых они развиваются как сапротрофы, или в виде живых тканей других организмов, на которых паразитируют. Растворенные в воде вещества поглощаются мицелием осмотическим путем всей его поверхностью или специализированными его частями. Такой способ питания называется диффузионно-осмотическим или осмотрофией. Грибы встречаются везде, где есть растительные остатки, например опавшие листья, разрушающаяся древесина, остатки животных, и вызывают их разложение и минерализацию, а также образование гумуса. Таким образом, грибы являются редуцентами (т. е. разрушителями), как бактерии и некоторые другие организмы. Сапротрофы обычно относительно мало специализированы в отношении питания. Доступность для них тех или иных органических соединений сложного строения — полисахаридов, белков и др. определяется способностью таких грибов синтезировать и выделять в окружающую среду ферменты, разлагающие эти вещества на более простые компоненты — простые сахара, аминокислоты и др. По этой способности грибы сильно различаются: одни из них способны использовать только простые углеводы, органические кислоты, спирты и др. (их часто называют сахарные грибы), а другие образуют гидролитические ферменты, разлагающие крахмал, целлюлозу, белки, хитин и др., и могут развиваться на субстратах, содержащих эти вещества. Поэтому в процессе разложения растительных остатков, например опада или древесины, наблюдается закономерная смена одних видов грибов другими, получившая название сукцессии (см. гл. 7). Среди сапротрофов мы иногда встречаем и довольно узко специализированные группы, например кератинофилы, разлагающие очень стойкий белок животного происхождения кератин, и развивающиеся на содержащих его остатках — копытах, рогах, птичьих перьях, волосах и т. п.. Однако специализация этих грибов определяется в основном их малой способностью к конкуренции за питание с другими, более быстро растущими или образующими антибиотики микроорганизмами. Такие грибы уходят от конкуренции, занимая специфические субстраты, недоступные для других организмов. Большинство микологов считают, что сапротрофный способ питания для грибов первичен, а паразитизм — это один из путей их специализации при уходе от конкуренции. Существует более 10 000 видов грибов-паразйтов, поэтому не удивительно, что эта группа крайне разнообразна по образу жизни. Грибы паразитируют на самых разных организмах — на растениях, начиная от водорослей и кончая цветковыми, на многочисленных беспозвоночных (например, насекомых), позвоночных животных и на человеке, на других грибах и лишайниках. Одни виды паразитов развиваются только на строго определенных хозяевах, часто одного или близких видов, т. е. обладают узкой специализацией, например ржавчинные грибы. Другие, наоборот, могут поражать широкий круг хозяев, относящихся даже к разным семействам растений, а иногда и к разным царствам органического мира. Так, ботритис серый — возбудитель серой плесени поражает ландыш, тюльпаны, пионы, землянику, малину и многие другие растения, а недавно он был обнаружен и на плодовых телах шляпочных грибов; один из вертициллов паразитирует и на насекомых, и на грибах. Среди грибов есть и факультативные паразиты, развивающиеся обычно сапротрофно, но способные паразитировать на ослабленных растениях или на невегетирующих их частях, например плодах, и факультативные сапротрофы-паразиты, способные к сапротрофному существованию в почве или на растительных остатках. Наконец, существуют обязательные, или облигатные, паразиты, обитающие только на живых организмах. Некоторые, из них, например мучнисторосяные, не способны расти на искусственных питательных средах, другие, например, ржавчинные грибы, могут развиваться на них и даже образуют в этих условиях типичные спороношения — уредоспоры и телейтоспоры. Развиваясь в организме хозяина, разные паразиты по-разному действуют на него. Одни из них, называемые некротрофами, сначала убивают ткани хозяина своими ферментами или ядовитыми веществами — токсинами, а затем уже питаются ими. Другие, биотрофы, могут питаться только за счет живых тканей хозяина и долго не вызывают их гибели. Однако провести четкую грань между некротрофами и биотрофами невозможно, так как известны грибы, начинающие свое развитие как биотрофы, на живом хозяине, а затем переходящие к некротрофному питанию. Многие микологи предполагают, что к биотрофным паразитам близки по происхождению и так называемые симбиотрофные грибы, живущие в тесной взаимовыгодной связи с зелеными растениями. В таком комплексе гриба с водорослью (в лишайниках) или с корнями высших растений (микоризах) происходит прижизненный обмен веществами, необходимыми обоим симбионтам.Влияние внешних условий на развитие грибов
Для развития грибов присутствия подходящего субстрата — опавших листьев, живых растений и др. недостаточно, необходимо также определенное сочетание условий среды — температуры, влажности, освещения и др. При этом часто для роста мицелия и образования спороношений нужны разные условия. Известно, что переход от вегетативного роста к образованию спор часто связан у грибов с изменением условий питания и происходит после истощения ими среды. При росте на богатых органическими веществами средах, например пивном сусле, многие микроскопические грибы (альтернарии, пенициллы и др.) пышно растут, но плохо спороносят и, наоборот, на средах бедных органикой образуют обильные спороношения. Для роста мицелия многих шляпочных грибов нужна более высокая температура, чем для образования их плодовых тел. Так, у культивируемого шампиньона мицелий лучше растет при температуре 20 — 2 5°С, а плодовые тела образуются при 15-18°С. Грибы способны развиваться в широких пределах температуры. Рост многих из них начинается при 0-5°С и прекращается только при повышении температуры до 3 5-40°С, но наиболее благоприятны для них 20 — 30°С. Большинство наших распространенных шляпочных грибов плодоносит при 15-22° С. Есть, однако, грибы, которые лучше развиваются при более низких и при более высоких температурах. У первых из них, называемых психрофилами, развитие происходит обычно ранней весной или поздней осенью, а часто продолжается и всю зиму. Так, плодовые тела сморчков и строчков образуются ранней весной, при низких температурах, а у саркосомы и саркосцифы — часто на проталинах, рядом с еще не растаявшим снегом. После осенних заморозков еще продолжают плодоносить некоторые шляпочные грибы; вешенку, фиолетовую рядовку, зимний гриб, некоторые гигрофорусы можно встретить до глубокой осени. Саркосцифа часто появляется рано весной
У перечисленных видов психрофилия проявляется на стадии плодоношения, а их мицелий прекраснорастет и при температуре около 20°С. Известны грибы, весь цикл развития которых может происходить при низких температурах, не превышающих 5-10°С. В северных районах возделывания озимых на них часто распространяется снежная плесень, вызывающая выпревание растений и образование на посевах характерных плешин. Возбудитель этой болезни — фузариум снежный — часто заражает растения еще с осени и развивается даже под снегом, если он выпал на незамерзшую почву. Ранней весной сразу после таяния снега можно наблюдать массовое образование на больных растениях рыхлого паутинистого мицелия со спорами.
Саркосцифа часто появляется рано весной
У перечисленных видов психрофилия проявляется на стадии плодоношения, а их мицелий прекраснорастет и при температуре около 20°С. Известны грибы, весь цикл развития которых может происходить при низких температурах, не превышающих 5-10°С. В северных районах возделывания озимых на них часто распространяется снежная плесень, вызывающая выпревание растений и образование на посевах характерных плешин. Возбудитель этой болезни — фузариум снежный — часто заражает растения еще с осени и развивается даже под снегом, если он выпал на незамерзшую почву. Ранней весной сразу после таяния снега можно наблюдать массовое образование на больных растениях рыхлого паутинистого мицелия со спорами.
 Плодовые тела зимнего гриба, или зимнего опенка, растут даже зимой во время оттепели
При низких температурах способен развиваться и возбудитель так называемого снежного шютте — болезни сеянцев сосен, вызывающей часто гибель в питомниках до 60% растений. Заражение хвои этим грибом и его развитие происходят только зимой, под снежным покровом, где температура не опускается ниже -5°С. Ветви или целые сеянцы, находящиеся под снегом, при массовом развитии гриба погибают, поэтому болезнь особенно вредоносна в тех районах, где за зиму образуется мощный снежный покров.
Термофильные (теплолюбивые) грибы, часто встречающиеся в саморазогревающихся субстратах — компосте, гниющем сене и т. п., наоборот, требуют для своего развития высоких температур, от 30- 35 до 55°С и даже выше. Споры грибов могут нередко выдерживать действие очень высоких (более 90°С) и очень низких (менее — 200°С) температур, не теряя способности к прорастанию. Есть экспериментальные данные, подтверждающие, что часть клеток дрожжей не погибает при температуре более 80°С, а мицелий некоторых мукоров — при охлаждении его до -110°С. На способности грибов сохранять жизнеспособность при низких температурах основано хранение их спор и мицелия в жидком азоте, при — 196°С, широко используемое в коллекциях культур.
Большинство грибов требует для своего развития достаточно высокой влажности воздуха и субстрата. Так, многие макромицеты, в том числе шляпочные грибы и трутовики, хорошо развиваются и плодоносят при влажности выше 60% и особенно при 80-85%. При более высокой влажности субстрата (до 95-100%) их рост часто задерживается, так как в этих условиях возникает недостаток кислорода, необходимого для развития. Например, у древоразрушающих грибов при полном насыщении древесины водой мицелий не проникает внутрь ее, а стелется по ее поверхности и развит слабо. Почвы, насыщенные водой, например заболоченные, содержат лишь следы сво6одного кислорода. В таких почвах можно обнаружить лишь немногочисленные грибы, приспособленные к обитанию при недостатке кислорода, — эмерицеллопсисы, некоторые фузариумы и др. Особенно неблагоприятна высокая влажность в сочетании с низкой температурой для плодоношения многих шляпочных грибов. В холодное, дождливое лето бывают такие же небольшие урожаи грибов, как и в сухое. Для роста и образования плодоношений не всем грибам нужна высокая влажность. Не нуждаются в ней виды грибов, растущие в степях, пустынях и полупустынях, например некоторые гастеромицеты — баттарея, тулостома, феллориния и др. В процессе эволюции у таких грибов возникли специальные приспособления к условиям низкой влажности: толстый перидий плодовых тел, часто имеющий студенистый слой, мицелиальные тяжи и ризоморфы, способные проникать в глубокие слои почвы, а также песчаные чехлы вокруг них, сцементированные выделениями мицелия и образующие капилляры, по которым к мицелию поступает вода.
Мучнисторосяные грибы также предпочитают условия относительно невысокой влажности и особенно многочисленными бывают в годы с теплым и сухим летом. К обитанию в засушивых районах — в Средней Азии, степном Крыму, а также в южных районах Северной Америки и т. п. приспособились виды левейюла. Мицелий у них в отличие от других грибов этой группы развивается внутри тканей растений, а на поверхность через устьица выходят гифы, образующие конидиеносцы с конидиями. При массовом развитии в стадии конидиального спороношения эти грибы часто придают характерный вид пейзажу — пораженные растения выглядят как бы запыленными.
При крайне низкой влажности воздуха могут расти и некоторые аспергиллы. Ползучий эуроциум, например, встречается в хранилищах при влажности воздуха около 13 -15%, где вызывает плесневение зерна и других продуктов.
Мицелий грибов, распространяющийся в толще субстрата, прекрасно растет при отсутствии света. Солнечный свет даже подавляет у некоторых видов его развитие, или их мицелий обладает отрицательным фототропизмом (ростом в направлении от источника света). Отрицательный фототропизм вместе с явлением хемотропизма (роста в направлении увеличения концентрации определенных веществ) и гидротропизма обеспечивает рост мицелия внутри субстрата и его более полное использование.
Спороношения некоторых грибов, например плодовые тела шампиньонов, могут развиваться в условиях полной темноты. Известны случаи, когда они росли под асфальтом или бетонным полом и разрывали их, выходя на поверхность. Однако у большинства грибов нормальное спороношение происходит только при освещении. Сейчас установлено, что лучи определенных частей солнечного спектра — ультрафиолетовые и коротковолновые синие — индуцируют образование спор у грибов, например у альтернарий, фузариумов и др. Обнаружены у грибов и некоторые пигменты-фоторецепторы (воспринимающие свет). У многих шляпочных грибов и трутовиков, развивающихся в темноте или при недостатке света, плодовые тела часто имеют уродливую форму, у них отсутствует дифференциация на шляпку и ножку и не образуются споры.
Солнечный свет, особенно ультрафиолетовые лучи, в больших дозах подавляет развитие грибов, даже убивает их. Это явление получило название светового повреждения или световой гибели. Поэтому у грибов, подверженных в условиях их местообитания (в горах, пустынях, на поверхности растений и т. д.) сильной инсоляции, возникли приспособления для защиты от нее. В клеточных стенках этих грибов содержатся темные пигменты — меланины, поглощающие свет и защищающие от его действия клеточные структуры. Защитные функции выполняют и красные или оранжевые пигменты из группы каротиноидов, образуемые многими грибами.
Очень важное значение для развития организмов имеет активная кислотность среды (рН), величина которой характеризует концентрацию в среде ионов водорода; от ее значения зависит жизнь грибов — поступление в клетку питательных веществ, активность ферментов, спорообразование, синтез пигментов и антибиотиков и др.
Большинство грибов предпочитает для своего развития субстраты, имеющие кислую реакцию, — растительные остатки и ткани растений, кислые почвы и др. Меньше грибов на животных остатках и других субстратах, имеющих щелочную реакцию. На них в массе развиваются бактерии и актиномицеты, которые, наоборот, не растут при кислой реакции среды.
Изучение грибов в чистой культуре показывает, что оптимальна для них кислая среда, однако предельные значения кислотности для разных грибов различны. Некоторые виды пенициллов и аспергиллов, например, могут развиваться в очень широких пределах кислотности — от сильнокислой до щелочной среды (рН от 1,5-2 до 11). Кроме того, начиная свой рост в щелочных условиях, грибы могут активно изменять реакцию среды в кислую стороны за счет образования углекислого газа и органических кислот. Поэтому предпочтение грибами кислых субстратов связано не только с более подходящей для их роста реакцией среды, но и, вероятно, в большей мере с отсутствием или слабым развитием в таких субстратах их основных конкурентов — бактерий и актиномицетов.
На любых естественных субстратах, будь то почвы, растительные остатки, поверхность растений и т. п., грибы не развиваются в чистой культуре, а встречаются в очень сложных группировках или сообществах, в состав которых входят другие микроорганизмы (бактерии, актиномицеты), а также микроскопические животные — амебы и другие простейшие, нематоды, насекомые и др., вступают также во взаимодействие с растениями и животными. В таких группировках существуют очень сложные взаимодействия между входящими в их состав организмами: от отрицательных, подавляющих развитие организмов — конкуренции за источники питания или воду, выделения продуктов обмена, подавляющих рост других организмов (антибиоз), до положительных, благоприятных для организмов — образования одними организмами веществ, используемых в пищу другими организмами (метабиоз), или симбиотических отношений. Некоторые грибы, обладающие вследствие медленного роста или по другим причинам слабой конкурентной способностью, часто развиваются в таких условиях и на таких субстратах, где конкурентные организмы отсутствуют. Таковы, например, многочисленные карбофильные грибы, растущие на гарях и кострищах. Их можно встретить на свежих кострищах уже через 10-12 дней. Первыми на них развиваются красно-оранжевые корочки сливающихся апотециев пиронемы, позднее появляются геопиксисы и некоторые пецицы, сморчки, а затем специфические шляпочные грибы (чешуйчатка огнелюбивая и др.) и печеночные мхи.
Развитие грибов в значительной мере зависит от деятельности человека. Мы уже упоминали, что человек часто переносит пропагулы грибов, способствуя их распространению. К сожалению, это касается преимущественно грибов-паразитов, вызывающих болезни растений. В процессе освоения новых пространств коренным образом меняются условия среды, и это неизбежно отражается на развитии грибов. Там, где нет леса, уже не встретишь грибов, образующих микоризу с деревьями — белых, подосиновиков, подберезовиков, рыжиков и др. В окультуренных почвах, в противоположность лесным резко сокращается содержание базидиальных грибов, зато развивается множество таких микроскопических грибов, как пенициллы, аспергиллы, фузариумы и др.
Резко нарушается развитие грибов, особенно шляпочных, и в лесах, где пасут скот, или подверженных сильной рекреационной нагрузке, которая особенно сильна в лесах лесопарковых зон крупных городов. При сильном вытаптывании уплотняется почва, изменяется травяной покров, а вслед за этим и состав грибов. Кроме того, много мицелия уничтожается при варварском сборе грибов, когда грибники буквально разворачивают лесную подстилку в поисках совсем крошечных, еще не вышедших на поверхность плодовых тел. От рук отдыхающих немало гибнет и несъедобных грибов — сбитых или раздавленных мухоморов и других поганок. Такому "грибнику" и невдомек, что ненужные ему грибы — необходимые компоненты сложного сообщества, каким является лес, участвующие в минерализации опада, образующие микоризу с деревьями, служащие пищей для многочисленных животных.
Плодовые тела зимнего гриба, или зимнего опенка, растут даже зимой во время оттепели
При низких температурах способен развиваться и возбудитель так называемого снежного шютте — болезни сеянцев сосен, вызывающей часто гибель в питомниках до 60% растений. Заражение хвои этим грибом и его развитие происходят только зимой, под снежным покровом, где температура не опускается ниже -5°С. Ветви или целые сеянцы, находящиеся под снегом, при массовом развитии гриба погибают, поэтому болезнь особенно вредоносна в тех районах, где за зиму образуется мощный снежный покров.
Термофильные (теплолюбивые) грибы, часто встречающиеся в саморазогревающихся субстратах — компосте, гниющем сене и т. п., наоборот, требуют для своего развития высоких температур, от 30- 35 до 55°С и даже выше. Споры грибов могут нередко выдерживать действие очень высоких (более 90°С) и очень низких (менее — 200°С) температур, не теряя способности к прорастанию. Есть экспериментальные данные, подтверждающие, что часть клеток дрожжей не погибает при температуре более 80°С, а мицелий некоторых мукоров — при охлаждении его до -110°С. На способности грибов сохранять жизнеспособность при низких температурах основано хранение их спор и мицелия в жидком азоте, при — 196°С, широко используемое в коллекциях культур.
Большинство грибов требует для своего развития достаточно высокой влажности воздуха и субстрата. Так, многие макромицеты, в том числе шляпочные грибы и трутовики, хорошо развиваются и плодоносят при влажности выше 60% и особенно при 80-85%. При более высокой влажности субстрата (до 95-100%) их рост часто задерживается, так как в этих условиях возникает недостаток кислорода, необходимого для развития. Например, у древоразрушающих грибов при полном насыщении древесины водой мицелий не проникает внутрь ее, а стелется по ее поверхности и развит слабо. Почвы, насыщенные водой, например заболоченные, содержат лишь следы сво6одного кислорода. В таких почвах можно обнаружить лишь немногочисленные грибы, приспособленные к обитанию при недостатке кислорода, — эмерицеллопсисы, некоторые фузариумы и др. Особенно неблагоприятна высокая влажность в сочетании с низкой температурой для плодоношения многих шляпочных грибов. В холодное, дождливое лето бывают такие же небольшие урожаи грибов, как и в сухое. Для роста и образования плодоношений не всем грибам нужна высокая влажность. Не нуждаются в ней виды грибов, растущие в степях, пустынях и полупустынях, например некоторые гастеромицеты — баттарея, тулостома, феллориния и др. В процессе эволюции у таких грибов возникли специальные приспособления к условиям низкой влажности: толстый перидий плодовых тел, часто имеющий студенистый слой, мицелиальные тяжи и ризоморфы, способные проникать в глубокие слои почвы, а также песчаные чехлы вокруг них, сцементированные выделениями мицелия и образующие капилляры, по которым к мицелию поступает вода.
Мучнисторосяные грибы также предпочитают условия относительно невысокой влажности и особенно многочисленными бывают в годы с теплым и сухим летом. К обитанию в засушивых районах — в Средней Азии, степном Крыму, а также в южных районах Северной Америки и т. п. приспособились виды левейюла. Мицелий у них в отличие от других грибов этой группы развивается внутри тканей растений, а на поверхность через устьица выходят гифы, образующие конидиеносцы с конидиями. При массовом развитии в стадии конидиального спороношения эти грибы часто придают характерный вид пейзажу — пораженные растения выглядят как бы запыленными.
При крайне низкой влажности воздуха могут расти и некоторые аспергиллы. Ползучий эуроциум, например, встречается в хранилищах при влажности воздуха около 13 -15%, где вызывает плесневение зерна и других продуктов.
Мицелий грибов, распространяющийся в толще субстрата, прекрасно растет при отсутствии света. Солнечный свет даже подавляет у некоторых видов его развитие, или их мицелий обладает отрицательным фототропизмом (ростом в направлении от источника света). Отрицательный фототропизм вместе с явлением хемотропизма (роста в направлении увеличения концентрации определенных веществ) и гидротропизма обеспечивает рост мицелия внутри субстрата и его более полное использование.
Спороношения некоторых грибов, например плодовые тела шампиньонов, могут развиваться в условиях полной темноты. Известны случаи, когда они росли под асфальтом или бетонным полом и разрывали их, выходя на поверхность. Однако у большинства грибов нормальное спороношение происходит только при освещении. Сейчас установлено, что лучи определенных частей солнечного спектра — ультрафиолетовые и коротковолновые синие — индуцируют образование спор у грибов, например у альтернарий, фузариумов и др. Обнаружены у грибов и некоторые пигменты-фоторецепторы (воспринимающие свет). У многих шляпочных грибов и трутовиков, развивающихся в темноте или при недостатке света, плодовые тела часто имеют уродливую форму, у них отсутствует дифференциация на шляпку и ножку и не образуются споры.
Солнечный свет, особенно ультрафиолетовые лучи, в больших дозах подавляет развитие грибов, даже убивает их. Это явление получило название светового повреждения или световой гибели. Поэтому у грибов, подверженных в условиях их местообитания (в горах, пустынях, на поверхности растений и т. д.) сильной инсоляции, возникли приспособления для защиты от нее. В клеточных стенках этих грибов содержатся темные пигменты — меланины, поглощающие свет и защищающие от его действия клеточные структуры. Защитные функции выполняют и красные или оранжевые пигменты из группы каротиноидов, образуемые многими грибами.
Очень важное значение для развития организмов имеет активная кислотность среды (рН), величина которой характеризует концентрацию в среде ионов водорода; от ее значения зависит жизнь грибов — поступление в клетку питательных веществ, активность ферментов, спорообразование, синтез пигментов и антибиотиков и др.
Большинство грибов предпочитает для своего развития субстраты, имеющие кислую реакцию, — растительные остатки и ткани растений, кислые почвы и др. Меньше грибов на животных остатках и других субстратах, имеющих щелочную реакцию. На них в массе развиваются бактерии и актиномицеты, которые, наоборот, не растут при кислой реакции среды.
Изучение грибов в чистой культуре показывает, что оптимальна для них кислая среда, однако предельные значения кислотности для разных грибов различны. Некоторые виды пенициллов и аспергиллов, например, могут развиваться в очень широких пределах кислотности — от сильнокислой до щелочной среды (рН от 1,5-2 до 11). Кроме того, начиная свой рост в щелочных условиях, грибы могут активно изменять реакцию среды в кислую стороны за счет образования углекислого газа и органических кислот. Поэтому предпочтение грибами кислых субстратов связано не только с более подходящей для их роста реакцией среды, но и, вероятно, в большей мере с отсутствием или слабым развитием в таких субстратах их основных конкурентов — бактерий и актиномицетов.
На любых естественных субстратах, будь то почвы, растительные остатки, поверхность растений и т. п., грибы не развиваются в чистой культуре, а встречаются в очень сложных группировках или сообществах, в состав которых входят другие микроорганизмы (бактерии, актиномицеты), а также микроскопические животные — амебы и другие простейшие, нематоды, насекомые и др., вступают также во взаимодействие с растениями и животными. В таких группировках существуют очень сложные взаимодействия между входящими в их состав организмами: от отрицательных, подавляющих развитие организмов — конкуренции за источники питания или воду, выделения продуктов обмена, подавляющих рост других организмов (антибиоз), до положительных, благоприятных для организмов — образования одними организмами веществ, используемых в пищу другими организмами (метабиоз), или симбиотических отношений. Некоторые грибы, обладающие вследствие медленного роста или по другим причинам слабой конкурентной способностью, часто развиваются в таких условиях и на таких субстратах, где конкурентные организмы отсутствуют. Таковы, например, многочисленные карбофильные грибы, растущие на гарях и кострищах. Их можно встретить на свежих кострищах уже через 10-12 дней. Первыми на них развиваются красно-оранжевые корочки сливающихся апотециев пиронемы, позднее появляются геопиксисы и некоторые пецицы, сморчки, а затем специфические шляпочные грибы (чешуйчатка огнелюбивая и др.) и печеночные мхи.
Развитие грибов в значительной мере зависит от деятельности человека. Мы уже упоминали, что человек часто переносит пропагулы грибов, способствуя их распространению. К сожалению, это касается преимущественно грибов-паразитов, вызывающих болезни растений. В процессе освоения новых пространств коренным образом меняются условия среды, и это неизбежно отражается на развитии грибов. Там, где нет леса, уже не встретишь грибов, образующих микоризу с деревьями — белых, подосиновиков, подберезовиков, рыжиков и др. В окультуренных почвах, в противоположность лесным резко сокращается содержание базидиальных грибов, зато развивается множество таких микроскопических грибов, как пенициллы, аспергиллы, фузариумы и др.
Резко нарушается развитие грибов, особенно шляпочных, и в лесах, где пасут скот, или подверженных сильной рекреационной нагрузке, которая особенно сильна в лесах лесопарковых зон крупных городов. При сильном вытаптывании уплотняется почва, изменяется травяной покров, а вслед за этим и состав грибов. Кроме того, много мицелия уничтожается при варварском сборе грибов, когда грибники буквально разворачивают лесную подстилку в поисках совсем крошечных, еще не вышедших на поверхность плодовых тел. От рук отдыхающих немало гибнет и несъедобных грибов — сбитых или раздавленных мухоморов и других поганок. Такому "грибнику" и невдомек, что ненужные ему грибы — необходимые компоненты сложного сообщества, каким является лес, участвующие в минерализации опада, образующие микоризу с деревьями, служащие пищей для многочисленных животных.
 При бережном отношении к лесу можно сохранить высокие урожаи грибов даже при частом посещении его отдыхающими и грибниками. Давно известно, что многие грибы растут в основном на опушках и вдоль лесных дорог, а в лесной чаще их меньше
Предпринимались попытки повысить урожай грибов путем внесения в лесную почву удобрений. Экспериментами, проведенными в березовых и сосновых лесах Карелии, были выявлены интересные закономерности действия удобрений на плодоношение разных видов грибов. Внесение их в почву раз в 4-5 лет стимулировало плодоношение у одних видов грибов и полностью подавляло у других. В березняках, например, уже в первый год после добавления к почве азота или полного удобрения появлялись черные грузди и свинушка тонкая, а на второй год последняя развилась так сильно, что составила 90% всего урожая грибов. В то же время на таких участках почти совсем пропали белые грибы, паутинники и некоторые другие, урожай которых не восстановился даже через 4 года после внесения удобрений.
При бережном отношении к лесу можно сохранить высокие урожаи грибов даже при частом посещении его отдыхающими и грибниками. Давно известно, что многие грибы растут в основном на опушках и вдоль лесных дорог, а в лесной чаще их меньше
Предпринимались попытки повысить урожай грибов путем внесения в лесную почву удобрений. Экспериментами, проведенными в березовых и сосновых лесах Карелии, были выявлены интересные закономерности действия удобрений на плодоношение разных видов грибов. Внесение их в почву раз в 4-5 лет стимулировало плодоношение у одних видов грибов и полностью подавляло у других. В березняках, например, уже в первый год после добавления к почве азота или полного удобрения появлялись черные грузди и свинушка тонкая, а на второй год последняя развилась так сильно, что составила 90% всего урожая грибов. В то же время на таких участках почти совсем пропали белые грибы, паутинники и некоторые другие, урожай которых не восстановился даже через 4 года после внесения удобрений.
Принципы классификации грибов
Классификация — это подразделение организмов на четкие, хорошо различимые группы — таксоны. Эти группы располагаются в порядке иерархии в определенно упорядоченной системе, т. е. они взаимоподчинены и имеют разные уровни — ранги. Хотя грибы и выделяют сейчас в самостоятельный таксон высшего ранга — царство, в период становления их системы их считали растениями, поэтому в системе грибов мы встречаем те же таксоны, что и у растений: • отдел; • класс; • порядок; • семейство; • род; • вид. Для того чтобы выделить такие группы, нужно выбрать те признаки, которые их объединяют или разделяют — таксономические признаки. От выбора зависит, какой характер будет иметь созданная система, отразит ли она лишь внешнее сходство организмов или сумеет уловить их действительное родство. Часто классификация по какому-либо хорошо заметному признаку приводит к выделению очень разнородных групп, имеющих, кроме сходства по этому признаку, очень мало общего. Примером может служить классификация Плинием грибов на съедобные и несъедобные. Эта классификация, использовавшая, важный для человека признак — съедобность, ничего не говорила ни о морфологии, внешнем виде, ни о других особенностях грибов. Такие классификации, основанные на одном или немногих удобных, но произвольно взятых признаках, называют искусственными. С развитием микологии систему грибов стали строить на совокупности признаков, но и в этом случае нередко в одну группу попадали организмы, сходные внешне, но различающиеся по происхождению. Пример этого — выделение на основании уровня развития вегетативного тела классов архимицеты и фикомицеты, принятое в систематике грибов еще 15-2 0 лет назад. Первый из них характеризуется отсутствием настоящего мицелия, а второй — хорошо развитым неклеточным мицелием. Эти классы объединили сходные эволюционные уровни организации вегетативного тела в разных филогенетических стволах грибов. Таксономические признаки для создания системы, заслуживающей названия филогенетической, должны удовлетворять главным условиям — быть эволюционно стабильными и характеризовать родственные связи организмов. Подбор таких признаков особенно труден у грибов, палеонтологические находки которых немногочисленны и относятся преимущественно к тем периодам, когда грибы уже достигли высокого уровня организации, близкого к современному. Поэтому в отличие от растений и животных все филогенетические построения у грибов основаны на сравнительных исследованиях ныне живущих форм. Основные таксономические признаки, используемые в систематике грибов, как и других групп организмов, — морфологические, т. е. признаки строения, включая и ультраструктуру, доступную только исследованиям при помощи электронного микроскопа. Однако набор таких признаков у многих групп грибов часто невелик, и они могут быть сходны у неродственных групп, обитающих в подобных условиях внешней среды. В связи с этим сейчас в систематике грибов широко используются и другие группы признаков — биохимические (характер обмена, образование тех или иных продуктов обмена и др.), генетические, экологические и т. д. Большое значение в последние годы придается такому признаку, как структура нуклеиновых кислот и в первую очередь ДНК, т. е. самого генетического материала.Таксономическая иерархия
В основе системы любой группы лежит важнейший таксон — вид. Каждый вид характеризуется, с одной стороны, достаточно выраженной целостностью, а с другой — обособленностью от других видов. В пределах вида мы часто наблюдаем очень большую изменчивость признаков, однако между отдельными вариантами, даже сильно различающимися между собой, всегда можно найти переходы. Например, варьируют окраска шляпки у красного мухомора или белого гриба, размеры плодовых тел и спор грибов и другие признаки. Поэтому при описании видов всегда отмечают пределы варьирования их признаков. Но если мы возьмем даже близкие между собой виды, то не найдем между ними переходных форм. Одна из важнейших особенностей видов — их дискретность (прерывистость). Каждый вид принадлежит к определенному роду. Роды состоят из видов, обладающих многими общими признаками и тесно связанных между собой родственными отношениями. Роды группируются в семейства, семейства — в порядки, порядки — в классы, классы в отделы, а отделы — в таксон наивысшего ранга — царство. Нередко вводятся и промежуточные таксоны, например в крупных и хорошо дифференцированных классах с многочисленными порядками выделяются подклассы. Разные уровни иерархии таксонов — это не только дань удобству пользования системой, но и отражение разной степени филогенетического, эволюционного родства. Например, отделы грибов Оомикота и Эумикота — это основные эволюционные стволы в царстве грибов, различающихся по происхождению, а классы — группы порядков, представляющие основные ветви филогенетических древ грибов. Научные названия видов, в отличие от названий всех других таксонов, состоят из двух слов, поэтому их называют бинарными, или биноминальными. Первое из этих слов — название рода, к которому принадлежит вид, а второе — видовой эпитет. Например, видовое название красного мухомора — Amanita muscaria. Amanita — это название большого рода шляпочных грибов, включающего, кроме упомянутого вида, бледную поганку и многочисленные другие мухоморы — пантерный, поганковидный, вонючий и др., a muscaria — видовой эпитет именно красного мухомора.Современная система грибов
Большинство микологов считают, что грибы представляют два самостоятельных эволюционных ствола, различающихся как по морфологии, так и по биохимическим особенностям. Этим эволюционным стволам соответствуют два отдела современной системы грибов: отдел Оомикота (Oomycota), хapактеризующийся подвижными стадиями с двумя жгутиками или одним перистым жгутиком и присутствием в стенках клеток целлюлозы, как у растений, и отдел Настоящие грибы, или Эумикота (Eumycota), — с подвижными стадиями, имеющими один гладкий бичевидный жгутик или чаще не имеющие вообще подвижных стадий; целлюлоза в их клеточных стенках отсутствует, и они содержат хитин. Отделы грибов различаются также по характеру обмена и по некоторым признакам ультраструктуры клеток. Попытки создания классификации грибов, отражающие те или иные их особенности, отражены на многих старинных рисунках и в названиях. Так, рисунок рогатика желтого имеет латинское название, передающее его строение (рамозус — ветвистый) и цвет (флавус — желтый)
Классы выделяются на основании характера органов размножения грибов, а также некоторых признаков строения их вегетативного тела. Отдел Оомикота относительно немногочислен и включает только два класса Оомицеты (Oomycetes) и Гифохитриомицеты (Hyphochytriomicetes), различающиеся количеством жгутиков и составом клеточных стенок: у второго из них в клеточных стенках наряду с целлюлозой обнаружен и хитин. Большинство грибов (более 95%) относится к отделу Эумикота, в котором выделяют пять классов:
1. Хитридиомицеты (Chytridiomycetes) с одноклеточным вегетативным телом или слаборазвитым мицелием и с подвижными стадиями, имеющими один бичевидный жгутик.
2. Зигомицеты (Zygomycetes) с хорошо развитым неклеточным мицелием и бесполым размножением спорангиоспорами; мейоспоры образуются в зародышевом спорангии.
3. Аскомицеты, или сумчатые грибы (Ascomycetes ), с хорошо развитым клеточным мицелием. Их мейоспоры образуются внутри специальных клеток — сумок, или асков, а митоспоры представлены конидиями.
4. Базидиомицеты, или базидиальные грибы (Basidiomycetes), также с хорошо развитым клеточным мицелием и бесполым размножением конидиями, однако мейоспоры образуются у них открыто на специальных клетках — базидиях.
5. Дейтеромицеты, или несовершенные грибы (Deuteromycetes), занимают среди грибов особое положение — размножаются только бесполым путем, конидиями. Эти грибы представляют собой "бывшие" аскомицеты или, реже, базидиомицеты, в процессе эволюции утратившие по тем или иным причинам половые спороношения. Поэтому класс Дейтеромицеты не соответствует классу в его обычном понимании — т. е. группе филогенетически близких порядков, связанных единством происхождения, а представляет разнородную в филогенетическом отношении группу — производное двух других классов.
Разобрав основные систематические группы грибов и правила номенклатуры, попытаемся найти место в системе для некоторых известных всем нам грибов — красного мухомора и сморчка обыкновенного, а также для одного из пенициллов — Penicillium chrysogenum, образующего антибиотик пенициллин.
Попытки создания классификации грибов, отражающие те или иные их особенности, отражены на многих старинных рисунках и в названиях. Так, рисунок рогатика желтого имеет латинское название, передающее его строение (рамозус — ветвистый) и цвет (флавус — желтый)
Классы выделяются на основании характера органов размножения грибов, а также некоторых признаков строения их вегетативного тела. Отдел Оомикота относительно немногочислен и включает только два класса Оомицеты (Oomycetes) и Гифохитриомицеты (Hyphochytriomicetes), различающиеся количеством жгутиков и составом клеточных стенок: у второго из них в клеточных стенках наряду с целлюлозой обнаружен и хитин. Большинство грибов (более 95%) относится к отделу Эумикота, в котором выделяют пять классов:
1. Хитридиомицеты (Chytridiomycetes) с одноклеточным вегетативным телом или слаборазвитым мицелием и с подвижными стадиями, имеющими один бичевидный жгутик.
2. Зигомицеты (Zygomycetes) с хорошо развитым неклеточным мицелием и бесполым размножением спорангиоспорами; мейоспоры образуются в зародышевом спорангии.
3. Аскомицеты, или сумчатые грибы (Ascomycetes ), с хорошо развитым клеточным мицелием. Их мейоспоры образуются внутри специальных клеток — сумок, или асков, а митоспоры представлены конидиями.
4. Базидиомицеты, или базидиальные грибы (Basidiomycetes), также с хорошо развитым клеточным мицелием и бесполым размножением конидиями, однако мейоспоры образуются у них открыто на специальных клетках — базидиях.
5. Дейтеромицеты, или несовершенные грибы (Deuteromycetes), занимают среди грибов особое положение — размножаются только бесполым путем, конидиями. Эти грибы представляют собой "бывшие" аскомицеты или, реже, базидиомицеты, в процессе эволюции утратившие по тем или иным причинам половые спороношения. Поэтому класс Дейтеромицеты не соответствует классу в его обычном понимании — т. е. группе филогенетически близких порядков, связанных единством происхождения, а представляет разнородную в филогенетическом отношении группу — производное двух других классов.
Разобрав основные систематические группы грибов и правила номенклатуры, попытаемся найти место в системе для некоторых известных всем нам грибов — красного мухомора и сморчка обыкновенного, а также для одного из пенициллов — Penicillium chrysogenum, образующего антибиотик пенициллин.
 Латинское название красного мухомора — аманита мускария,- как и названия его на многих других языках, показывают, что для мух этот гриб совсем не безразличен
Красный мухомор (Amanita muscaria), принадлежит к роду мухомор (Amanita), семейству мухоморовые (Amanitaceae) порядку агариковые (Agaricales ), классу базидиомицеты ( Basidiomycetes ) и отделу эумикота (Eumycota). Сморчок обыкновенный (Morchellaesculenta) относится к роду сморчок (Morchella), семейству сморчковые (Morchellaceae), порядку пецицовые (Pezizales), классу аскомицеты (Ascomycetes) и отделу эумикота (Eumycota). Пеницилл золотистопигментный (Penicillium chrysogenum) принадлежат к роду пеницилл (Penicillium), семейству монилиевые (Moniliaсеае), порядку гифальные, или гифомицеты (Hyphomycetales), классу дейтеромицеты (Deuteromycetes) и отделу эумикота (Eumycota).
Следует отметить, что так называемые макромицеты — грибы с крупными плодовыми телами, видимыми невооруженным глазом — это представители двух классов грибов — аскомицетов и базидиомицетов.
Латинское название красного мухомора — аманита мускария,- как и названия его на многих других языках, показывают, что для мух этот гриб совсем не безразличен
Красный мухомор (Amanita muscaria), принадлежит к роду мухомор (Amanita), семейству мухоморовые (Amanitaceae) порядку агариковые (Agaricales ), классу базидиомицеты ( Basidiomycetes ) и отделу эумикота (Eumycota). Сморчок обыкновенный (Morchellaesculenta) относится к роду сморчок (Morchella), семейству сморчковые (Morchellaceae), порядку пецицовые (Pezizales), классу аскомицеты (Ascomycetes) и отделу эумикота (Eumycota). Пеницилл золотистопигментный (Penicillium chrysogenum) принадлежат к роду пеницилл (Penicillium), семейству монилиевые (Moniliaсеае), порядку гифальные, или гифомицеты (Hyphomycetales), классу дейтеромицеты (Deuteromycetes) и отделу эумикота (Eumycota).
Следует отметить, что так называемые макромицеты — грибы с крупными плодовыми телами, видимыми невооруженным глазом — это представители двух классов грибов — аскомицетов и базидиомицетов.
Грибы на земном шаре
 Пожалуй, на земле не найдется такого места, где не росли бы грибы.
Утверждение о том, что грибы чрезвычайно широко распространены на земном шаре, справедливо, если говорить о макромицетах, т. е. о грибах, которые можно рассмотреть невооруженным глазом. Но если иметь в виду, что огромное большинство грибов — микромицеты, грибы, которые люди увидели впервые в XIX в., когда был изобретен микроскоп, тогда утверждение о "широком распространении" грибов не будет отвечать истине. Грибами буквально заселена наша планета!
В песках пустынь, в морях и океанах, на скалах, высоко в горах и в вечной темноте пещер живут грибы. Однако очень сложные и часто противоречивые факторы географического распределения грибов изучены еще недостаточно, и сведения, на основании которых можно было бы делать выводы о закономерностях этого распределения, далеко не полны.
Пожалуй, на земле не найдется такого места, где не росли бы грибы.
Утверждение о том, что грибы чрезвычайно широко распространены на земном шаре, справедливо, если говорить о макромицетах, т. е. о грибах, которые можно рассмотреть невооруженным глазом. Но если иметь в виду, что огромное большинство грибов — микромицеты, грибы, которые люди увидели впервые в XIX в., когда был изобретен микроскоп, тогда утверждение о "широком распространении" грибов не будет отвечать истине. Грибами буквально заселена наша планета!
В песках пустынь, в морях и океанах, на скалах, высоко в горах и в вечной темноте пещер живут грибы. Однако очень сложные и часто противоречивые факторы географического распределения грибов изучены еще недостаточно, и сведения, на основании которых можно было бы делать выводы о закономерностях этого распределения, далеко не полны.
Распространение грибов на земле
Изучая общие вопросы распространения грибов, легко прийти к выводу о том, что на них влияют в основном те же факторы, которыми определяется распространение живых организмов вообще. К этим факторам относятся климатические (температура, влажность, интенсивность осадков, освещенность и т. д.), пищевые (субстраты, за счет которых организмы питаются), состав атмосферы, в которой они развиваются, и взаимодействие с другими организмами — важнейший фактор, часто определяющий распространение живых организмов. Можно предположить, что на живые организмы влияют и такие пока еще недостаточно изученные факторы, как земной магнетизм, интенсивность космической радиации, атмосферное давление и др. Для грибов, питающихся готовыми органическими веществами, одним из основных факторов, определяющих их расселение, является наличие подходящего субстрата: гумусовой почвы, лесной подстилки, древесины и различных растительных остатков, а для паразитных грибов — наличие достаточного количества растений, на которых они могут паразитировать. Распространение микоризных грибов тесно связано с наличием симбионтного растения. Например, лиственничный масленок встречается по всему ареалу (области распространения) лиственницы. При переносе лиственницы в новые места обычно вместе с нею мигрирует и лиственничный масленок. Ареалы шляпочных грибов чаще сопутствуют не видам, а роду или даже нескольким родам растений, с которыми они имеют пищевые связи. Например, подосиновик, как об этом свидетельствует само название, состоит в симбиозе с осиной, возле которой его обычно находят, однако он встречается в симбиозе и с березой, что и определяет его обширный ареал. Редчайший пустынный гриб с ограниченным ареалом — симблюм круглоголовый
Большое значение для грибов имеют климатические условия. Есть теплолюбивые грибы тропических лесов; известны грибы пустынь и полупустынь, грибы, растущие в смешанных и широколиственных лесах, грибы — обитатели лугов и степей. Однако для грибов фактор климата все же имеет меньшее значение, чем для зеленых растений, в силу чего среди грибов мы встречаем особенно много космополитов, живущих в самых различных климатических поясах земного шара. Так, практически на всех континентах растет шампиньон обыкновенный, огромный ареал имеет белый гриб, произрастая на всех материках, за исключением Южной Америки и Австралии, а у нас он встречается от Кольского полуострова до Закавказья и от Карпат до Чукотки. Такое широкое распространение белого гриба, и не только его, объясняется, по-видимому, во-первых, тем, что он легко образует микоризу со многими древесными породами (около 50 видов), и, во-вторых, тем, что хорошо приспосабливается к самым различным климатическим условиям.
Редчайший пустынный гриб с ограниченным ареалом — симблюм круглоголовый
Большое значение для грибов имеют климатические условия. Есть теплолюбивые грибы тропических лесов; известны грибы пустынь и полупустынь, грибы, растущие в смешанных и широколиственных лесах, грибы — обитатели лугов и степей. Однако для грибов фактор климата все же имеет меньшее значение, чем для зеленых растений, в силу чего среди грибов мы встречаем особенно много космополитов, живущих в самых различных климатических поясах земного шара. Так, практически на всех континентах растет шампиньон обыкновенный, огромный ареал имеет белый гриб, произрастая на всех материках, за исключением Южной Америки и Австралии, а у нас он встречается от Кольского полуострова до Закавказья и от Карпат до Чукотки. Такое широкое распространение белого гриба, и не только его, объясняется, по-видимому, во-первых, тем, что он легко образует микоризу со многими древесными породами (около 50 видов), и, во-вторых, тем, что хорошо приспосабливается к самым различным климатическим условиям.
 Редчайший пустынный гриб с ограниченным ареалом — феллориния шишковатая
Существуют, однако, внешние факторы, ограничивающие распространение определенных видов грибов. Феллориния шишковатая, например, растет у нас только в пустынях Средней Азии и Казахстана. Довольно ограниченный ареал имеет и другой обитатель пустынь, особенно песчаных дюн морских побережий, — веселка Хадриана, которая растет при, казалось бы, невероятно высокой для гриба температуре, 55°С. Пока еще трудно определить, как сумел приспособиться этот гриб к таким экстремальным условиям существования: не только к высокой температуре, но и исключительно низкой влажности. Другой обитатель песчаных пустынь — сумчатый гриб сепултария пустынная — приспособился к условиям пустыни тем, что свое чашевидное тело диаметром в 7 см погрузил в песок, оставив снаружи лишь небольшую его часть, что уменьшило вероятность высыхания плодового тела этою гриба палящим солнцем.
Редчайший пустынный гриб с ограниченным ареалом — феллориния шишковатая
Существуют, однако, внешние факторы, ограничивающие распространение определенных видов грибов. Феллориния шишковатая, например, растет у нас только в пустынях Средней Азии и Казахстана. Довольно ограниченный ареал имеет и другой обитатель пустынь, особенно песчаных дюн морских побережий, — веселка Хадриана, которая растет при, казалось бы, невероятно высокой для гриба температуре, 55°С. Пока еще трудно определить, как сумел приспособиться этот гриб к таким экстремальным условиям существования: не только к высокой температуре, но и исключительно низкой влажности. Другой обитатель песчаных пустынь — сумчатый гриб сепултария пустынная — приспособился к условиям пустыни тем, что свое чашевидное тело диаметром в 7 см погрузил в песок, оставив снаружи лишь небольшую его часть, что уменьшило вероятность высыхания плодового тела этою гриба палящим солнцем.
 Гриб в горной тундре
Для теплолюбивых видов грибов фактором, ограничивающим их распространение, является, по-видимому, температура. Гриб фацидиум, например, паразитирующий на соснах, развивается при температуре не ниже 15...20°С, поэтому его ареал значительно уже ареала сосны, которая растет и при значительно более низких температурах. Следовательно, не распространение соответствующего субстрата, сосны, за счет которой фацидиум питается, а климатические и, в частности, температурные факторы оказываются в данном случае решающими в распространении этого гриба.
Гриб в горной тундре
Для теплолюбивых видов грибов фактором, ограничивающим их распространение, является, по-видимому, температура. Гриб фацидиум, например, паразитирующий на соснах, развивается при температуре не ниже 15...20°С, поэтому его ареал значительно уже ареала сосны, которая растет и при значительно более низких температурах. Следовательно, не распространение соответствующего субстрата, сосны, за счет которой фацидиум питается, а климатические и, в частности, температурные факторы оказываются в данном случае решающими в распространении этого гриба.
 Карбофильный гриб — омфалина гаревая
Иногда присутствие в определенной местности того или иного гриба, который может произрастать в климатических условиях, свойственных этой местности, зависит не только от наличия подходящего для него субстрата, но и от каких-либо особых, необходимых данному грибу условий. Так, некоторые почвенные сапротрофы — омфалина гаревая, пецица фиолетовая, чешуйчатка углелюбивая, или огневка, геопиксис угольный, а также некоторые коллибии растут только на гарях. Такое весьма своеобразное местообитание этих грибов вызвано тем, что рост их очень замедлен и, следовательно, они обладают весьма слабой конкурентной способностью по сравнению с другими грибами и бактериями. Поэтому растут там, где другие организмы отсутствуют и где почва простерилизована огнем. Эти грибы так и называются — карбофилы (от латинского "карбо" — уголь).
Карбофильный гриб — омфалина гаревая
Иногда присутствие в определенной местности того или иного гриба, который может произрастать в климатических условиях, свойственных этой местности, зависит не только от наличия подходящего для него субстрата, но и от каких-либо особых, необходимых данному грибу условий. Так, некоторые почвенные сапротрофы — омфалина гаревая, пецица фиолетовая, чешуйчатка углелюбивая, или огневка, геопиксис угольный, а также некоторые коллибии растут только на гарях. Такое весьма своеобразное местообитание этих грибов вызвано тем, что рост их очень замедлен и, следовательно, они обладают весьма слабой конкурентной способностью по сравнению с другими грибами и бактериями. Поэтому растут там, где другие организмы отсутствуют и где почва простерилизована огнем. Эти грибы так и называются — карбофилы (от латинского "карбо" — уголь).
 Карбофильный гриб — ризина вздутая на старых кострищах
Геопиксис угольный часто можно встретить весной и летом на кострищах, где он растет большими группами и имеет форму кубка на небольшой ножке. Этот гриб полезен, поскольку, заселяя места гарей, подготавливает почву для последующего ее заселения другими грибами, микроорганизмами и, наконец, высшими растениями. И все же решающим фактором распространения грибов является субстрат. Определив приуроченность видов грибов к определенным субстратам и выделив по этому признаку определенные экологические[1] группы, можно легче сориентироваться в расселении грибов на земном шаре.
Карбофильный гриб — ризина вздутая на старых кострищах
Геопиксис угольный часто можно встретить весной и летом на кострищах, где он растет большими группами и имеет форму кубка на небольшой ножке. Этот гриб полезен, поскольку, заселяя места гарей, подготавливает почву для последующего ее заселения другими грибами, микроорганизмами и, наконец, высшими растениями. И все же решающим фактором распространения грибов является субстрат. Определив приуроченность видов грибов к определенным субстратам и выделив по этому признаку определенные экологические[1] группы, можно легче сориентироваться в расселении грибов на земном шаре.
Экологические группы грибов
Наиболее обширные и важные экологические группы грибов — это ксилотрофы (от "ксилос" — древесина и "трофос" — питаться), обитающие на древесине, подстилочные и почвенные сапротрофы и микоризные грибы. Известно, что разложение древесины — одно из важнейших звеньев круговорота веществ в природе. Первенство в разрушении древесины принадлежит грибам-ксилотрофам, среди которых есть как паразиты, так и сапротрофы. Именно паразитные грибы начинают процесс разрушения древесины, поражая живые деревья. Два таких гриба-ксилопаразита особенно известны в силу их широкого распространения и того огромного вреда, который они причиняют лесу — это трутовик корневая губка, паразитирующий на хвойных деревьях, и шляпочный гриб опенок осенний. По мере разложения древесины корневую губку и опенок осенний сменяют другие ксилотрофы, например особенно часто встречающиеся у нас в лесах трутовики: настоящий с сероватым копытообразным плодовым телом и яркий — окаймленный. Грибница ксилосапротрофов разрастается в стволе обычно уже отмершего дерева, а плодовое тело образуется на поверхности. В течение всего периода разложения древесины одни грибы сменяют другие, образуя на разных стадиях разложения различные сообщества, состав которых зависит от породы дерева, влажности и температуры субстрата и т. д. Так, гриб дубовая губка растет на пнях и мертвых стволах дуба, бука, каштана, а также на обработанной древесине — досках, бревнах и т. д. Поселяясь уже на мертвой, но еще не разлагающейся древесине, эти грибы как бы начинают процесс ее разложения. Вслед за дубовой губкой на уже частично разложившейся древесине поселяются другие древоразрушающие грибы. Одни из самых распространенных из них — щелелистник обыкновенный, названный так потому, что с нижней стороны его плодового тела есть тонкие пурпурно-серые складочки, края которых при сухой погоде раздваиваются и прикрывают находящиеся на их боковых поверхностях споры. При влажной погоде края складочек выпрямляются, и спороносный слой открывается. Такая своеобразная защита спороносного слоя от сухого воздуха позволяет щелелистнику расти даже в полупустыне. Этим, очевидно, и объясняется его широкое распространение во всех частях света, где его можно найти на мертвых стволах, пнях, отмерших ветках лиственных и реже хвойных пород. 'Плачущий' трутовик окаймленный в стадии активного роста, когда на его поверхности выделяются капельки жидкости
Есть трутовики, растущие, на первый взгляд, на почве, но в действительности грибница их пронизывает валежник, находящийся в почве, а сами плодовые тела оказываются как бы лежащими на ее поверхности. К таким грибам относится сухлянка двухлетняя с мягким, тонким, как бы замшевым плодовым телом. Встречается она на земле и пнях в хвойных лесах. У нее очень тонкая ножка и бархатистая плоская или слегка воронкообразная желто-коричневая шляпка. Название свое гриб получил за то, что его плодовое тело хорошо сохраняется на второй год, становясь только немного темнее. Кроме трутовиков, на полуразложившейся древесине поселяются многие гастеромицеты. Это почти все виды гнездовковых с мелкими бокальчатыми плодовыми телами.
'Плачущий' трутовик окаймленный в стадии активного роста, когда на его поверхности выделяются капельки жидкости
Есть трутовики, растущие, на первый взгляд, на почве, но в действительности грибница их пронизывает валежник, находящийся в почве, а сами плодовые тела оказываются как бы лежащими на ее поверхности. К таким грибам относится сухлянка двухлетняя с мягким, тонким, как бы замшевым плодовым телом. Встречается она на земле и пнях в хвойных лесах. У нее очень тонкая ножка и бархатистая плоская или слегка воронкообразная желто-коричневая шляпка. Название свое гриб получил за то, что его плодовое тело хорошо сохраняется на второй год, становясь только немного темнее. Кроме трутовиков, на полуразложившейся древесине поселяются многие гастеромицеты. Это почти все виды гнездовковых с мелкими бокальчатыми плодовыми телами.
 Полуразложившаяся древесина — основное место обитания дождивика грушевидного
Типичный обитатель полуразложившейся древесины — дождевик грушевидный, растущий большими группами на различных гнилушках. Как и все дождевики, сначала он белого или кремового цвета, плотный, с белой мякотью, 1-3 см в диаметре, причем в этом возрасте съедобен.
Позже гриб приобретает бурую окраску, а содержимое его плодового тела превращается в порошок.
Полуразложившаяся древесина — основное место обитания дождивика грушевидного
Типичный обитатель полуразложившейся древесины — дождевик грушевидный, растущий большими группами на различных гнилушках. Как и все дождевики, сначала он белого или кремового цвета, плотный, с белой мякотью, 1-3 см в диаметре, причем в этом возрасте съедобен.
Позже гриб приобретает бурую окраску, а содержимое его плодового тела превращается в порошок.
 Полуразложившаяся древесина — основное место обитания гриба-дрожалки со студенистыми плодовыми телами
На валежных стволах растут грибы вешенки и многочисленные виды из рода чешуйчаток — активнейших разрушителей древесины. Одна из них так и называется чешуйчатка разрушающая. На стволах мертвых деревьев и особенно на пнях живут хорошо известные грибникам опенки летний, Кандолля, осенний, зимний и лжеопята серно-желтый, кирпично-красный. Все эти грибы объединяются одним экологическим признаком — растут на пнях. Отсюда и старое русское название "опенок", т. е. гриб, растущий "о пень" (около пня, на пне). В некоторых областях средней полосы РСФСР опенок осенний так и называют — пневый гриб или пневый опенок в отличие от лугового, растущего на лугах среди травы.
Полуразложившаяся древесина — основное место обитания гриба-дрожалки со студенистыми плодовыми телами
На валежных стволах растут грибы вешенки и многочисленные виды из рода чешуйчаток — активнейших разрушителей древесины. Одна из них так и называется чешуйчатка разрушающая. На стволах мертвых деревьев и особенно на пнях живут хорошо известные грибникам опенки летний, Кандолля, осенний, зимний и лжеопята серно-желтый, кирпично-красный. Все эти грибы объединяются одним экологическим признаком — растут на пнях. Отсюда и старое русское название "опенок", т. е. гриб, растущий "о пень" (около пня, на пне). В некоторых областях средней полосы РСФСР опенок осенний так и называют — пневый гриб или пневый опенок в отличие от лугового, растущего на лугах среди травы.
 Сухлянка двухлетняя активно разлагает мелкий валежник, находящийся под лесной подстилкой
Подстилочные сапротрофы, грибница которых не проникает в почву, а пронизывает листовый опад, связывая опавшую листву или остатки травянистого покрова в единую массу и разлагая ее, играют важную роль в почвообразовании лесов, лугов и степей и поэтому эти грибы еще называют грибами опада. На опаде растут грибы из разных систематических групп и микроскопические и макроскопические, но преобладают все те же шляпочные из класса базидиальных порядка пластинчатых, или агариковых, в основном с небольшими плодовыми телами — мицены, коллибии, негниючники и др.
Сухлянка двухлетняя активно разлагает мелкий валежник, находящийся под лесной подстилкой
Подстилочные сапротрофы, грибница которых не проникает в почву, а пронизывает листовый опад, связывая опавшую листву или остатки травянистого покрова в единую массу и разлагая ее, играют важную роль в почвообразовании лесов, лугов и степей и поэтому эти грибы еще называют грибами опада. На опаде растут грибы из разных систематических групп и микроскопические и макроскопические, но преобладают все те же шляпочные из класса базидиальных порядка пластинчатых, или агариковых, в основном с небольшими плодовыми телами — мицены, коллибии, негниючники и др.
 Маразмиуссы, или негниюшки, растут на лесной подстилке и активно ее разлагают.
Мицены — это мелкие и хрупкие грибы с яркой, в виде колокольчика шляпкой, которые с ранней весны до поздней осени можно встретить на опавших прошлогодних листьях, остатках травянистых растений, гниющем валежнике или просто на земле. Но где бы они ни росли, везде мицены выполняют свою основную работу — разрушают листья и старую древесину. На старых, покрытых мхом пнях и валежнике большими группами растет мицена кровяноножковая, названная так потому, что при надломе ножки из нее вытекает красно-бурый сок.
Маразмиуссы, или негниюшки, растут на лесной подстилке и активно ее разлагают.
Мицены — это мелкие и хрупкие грибы с яркой, в виде колокольчика шляпкой, которые с ранней весны до поздней осени можно встретить на опавших прошлогодних листьях, остатках травянистых растений, гниющем валежнике или просто на земле. Но где бы они ни росли, везде мицены выполняют свою основную работу — разрушают листья и старую древесину. На старых, покрытых мхом пнях и валежнике большими группами растет мицена кровяноножковая, названная так потому, что при надломе ножки из нее вытекает красно-бурый сок.
 Мицелий пронизывает опад, лесную подстилку, отмершие части лвращая их луговых растений, превращая их в гумус
Коллибия получила свое название от греческого слова "коллибус" — маленькая монетка. У нас эти грибы называют денежками, поскольку их шляпка действительно очень похожа на маленькую монетку, особенно если смотреть на гриб сверху. Растет коллибия, как и мицена, на опавших листьях или земле среди травы и мхов, часто забирается на пни, а иногда поселяется на ослабленных, но еще живых деревьях и даже на шляпках других грибов. Вместе с бактериями коллибии активно участвуют в разложении лесной подстилки. Некоторые из этих грибов съедобны, например коллибии масляная и лесолюбивая с относительно крупными плодовыми телами (от 2 до 6 см в диаметре). Растут они в средней полосе с июня по октябрь на лесной подстилке, причем довольно большими группами.
Мицелий пронизывает опад, лесную подстилку, отмершие части лвращая их луговых растений, превращая их в гумус
Коллибия получила свое название от греческого слова "коллибус" — маленькая монетка. У нас эти грибы называют денежками, поскольку их шляпка действительно очень похожа на маленькую монетку, особенно если смотреть на гриб сверху. Растет коллибия, как и мицена, на опавших листьях или земле среди травы и мхов, часто забирается на пни, а иногда поселяется на ослабленных, но еще живых деревьях и даже на шляпках других грибов. Вместе с бактериями коллибии активно участвуют в разложении лесной подстилки. Некоторые из этих грибов съедобны, например коллибии масляная и лесолюбивая с относительно крупными плодовыми телами (от 2 до 6 см в диаметре). Растут они в средней полосе с июня по октябрь на лесной подстилке, причем довольно большими группами.
 Мицелий коллибий
На растительных остатках живет и еще один интересный сапротроф, характерный для степей, — степной белый гриб. Свое название он получил за окраску плодового тела, а относится к роду вешенок и селится в основании отмерших стеблей некоторых зонтичных растений из рода ферула. Особенно часто и обильно этот гриб встречается в пустынно-степных предгорьях Средней Азии. Здесь он хорошо знаком местному населению и широко употребляется в пищу.
Из микроскопических грибов к подстилочным сапротрофам, активно разлагающим растительные остатки, относятся многочисленные плесневые грибы: пенициллы, аспергиллы, головчатые плесени и др. Все эти грибы выполняют роль лесных санитаров: в процессе своей жизнедеятельности разрушают умершие растения, очищая лес, и освобождают питательные вещества, необходимые для роста живых растений.
Еще одна важнейшая экологическая группа грибов — почвенные сапротрофы, грибница которых находится под опадом, в перегнойном слое почвы, разлагая его на более простые составные части и улучшая таким образом лесную почву. К типичным почвенным сапротрофам относится многочисленная семья шампиньонов: полевой, обыкновенный, таблитчатый. Всего же этот род включает около 230 видов, из которых около 60 встречаются на территории нашей страны. Большинство шампиньонов съедобно, а шампиньон двуспоровый стал настоящей сельскохозяйственной культурой, выращиваемой более чем в 40 странах мира.
Мицелий коллибий
На растительных остатках живет и еще один интересный сапротроф, характерный для степей, — степной белый гриб. Свое название он получил за окраску плодового тела, а относится к роду вешенок и селится в основании отмерших стеблей некоторых зонтичных растений из рода ферула. Особенно часто и обильно этот гриб встречается в пустынно-степных предгорьях Средней Азии. Здесь он хорошо знаком местному населению и широко употребляется в пищу.
Из микроскопических грибов к подстилочным сапротрофам, активно разлагающим растительные остатки, относятся многочисленные плесневые грибы: пенициллы, аспергиллы, головчатые плесени и др. Все эти грибы выполняют роль лесных санитаров: в процессе своей жизнедеятельности разрушают умершие растения, очищая лес, и освобождают питательные вещества, необходимые для роста живых растений.
Еще одна важнейшая экологическая группа грибов — почвенные сапротрофы, грибница которых находится под опадом, в перегнойном слое почвы, разлагая его на более простые составные части и улучшая таким образом лесную почву. К типичным почвенным сапротрофам относится многочисленная семья шампиньонов: полевой, обыкновенный, таблитчатый. Всего же этот род включает около 230 видов, из которых около 60 встречаются на территории нашей страны. Большинство шампиньонов съедобно, а шампиньон двуспоровый стал настоящей сельскохозяйственной культурой, выращиваемой более чем в 40 странах мира.
 Грибы-микофилы облюбовали шляпочные грибы, на которых они растут и за счет которых питаются. Это в основном плесневые микроскопические грибы, но есть среди них и шляпочные, например астерофора паразитная
Только два вида шампиньонов ядовиты: желтокожий с белой гладкой шляпкой, желтеющий при прикосновении и растущий в лиственных лесах, парках, садах, на лугах, и пестрый с дымчато-сероватой чешуйчатой шляпкой, который встречается в степной и лесостепной зоне Украины.
Из числа гастеромицетов к почвенным сапротрофам относится дождевик шиповатый, распространенный во всей средней полосе в лесах, на лугах и степях. Его белая в молодом возрасте, влажная, слегка прохладная мякоть под прикрытием оболочки остается стерильной, поэтому при отсутствии перевязочных средств ее можно использовать в полевых условиях как пластырь при порезах и ушибах.
Долгое время даже специалисты микологи не могли понять, почему грибница многих шляпочных грибов без близкого соседства с деревьями остается бесплодной. И только в 70-е годы прошлого столетия было установлено, что грибы не просто растут по соседству с избранными деревьями, но что это соседство имеет большое значение. Есть старинная русская пословица: "леса нет и гриб не родится". Это своеобразное содружество деревьев и грибов, которое часто отождествляется с их названием (подосиновик, подберезовик, подвишень, подольшаник и т. д.), нашло научное обоснование в открытии явления микоризы.
Грибница многих почвенных грибов, как макроскопических, так и микроскопических, вступает в определенный контакт с корнями растений, особенно часто древесных, образуя сложный комплекс, называемый грибокорнем или микоризой. Микориза — один из видов симбиоза, охватывающего многочисленные группы грибов и высших растений — интереснейшее и очень сложное явление природы, играющее большую роль в жизни обоих компонентов.
Очень большую экологическую группу составляют грибы — паразиты зеленых растений, или фитопатогенные грибы, о которых будет рассказано далее.
Грибы-микофилы облюбовали шляпочные грибы, на которых они растут и за счет которых питаются. Это в основном плесневые микроскопические грибы, но есть среди них и шляпочные, например астерофора паразитная
Только два вида шампиньонов ядовиты: желтокожий с белой гладкой шляпкой, желтеющий при прикосновении и растущий в лиственных лесах, парках, садах, на лугах, и пестрый с дымчато-сероватой чешуйчатой шляпкой, который встречается в степной и лесостепной зоне Украины.
Из числа гастеромицетов к почвенным сапротрофам относится дождевик шиповатый, распространенный во всей средней полосе в лесах, на лугах и степях. Его белая в молодом возрасте, влажная, слегка прохладная мякоть под прикрытием оболочки остается стерильной, поэтому при отсутствии перевязочных средств ее можно использовать в полевых условиях как пластырь при порезах и ушибах.
Долгое время даже специалисты микологи не могли понять, почему грибница многих шляпочных грибов без близкого соседства с деревьями остается бесплодной. И только в 70-е годы прошлого столетия было установлено, что грибы не просто растут по соседству с избранными деревьями, но что это соседство имеет большое значение. Есть старинная русская пословица: "леса нет и гриб не родится". Это своеобразное содружество деревьев и грибов, которое часто отождествляется с их названием (подосиновик, подберезовик, подвишень, подольшаник и т. д.), нашло научное обоснование в открытии явления микоризы.
Грибница многих почвенных грибов, как макроскопических, так и микроскопических, вступает в определенный контакт с корнями растений, особенно часто древесных, образуя сложный комплекс, называемый грибокорнем или микоризой. Микориза — один из видов симбиоза, охватывающего многочисленные группы грибов и высших растений — интереснейшее и очень сложное явление природы, играющее большую роль в жизни обоих компонентов.
Очень большую экологическую группу составляют грибы — паразиты зеленых растений, или фитопатогенные грибы, о которых будет рассказано далее.
 Грибы-микофилы облюбовали шляпочные грибы, на которых они растут и за счет которых питаются. Это в основном плесневые микроскопические грибы, но есть среди них и шляпочные, например астерофора паразитная
Грибы, заселяющие и использующие для питания очень специфические, зачастую неожиданные субстраты, образуют ограниченные экологические группы. Например, микофильные грибы поселяются как паразиты на своих собратьях грибах, причем среди них есть и микроскопические, и макроскопические. Особенно часто этих паразитов можно встретить на плодовых телах шляпочных грибов и трутовиков в виде белых, сероватых или другой окраски пленок, покрывающих поверхность шляпок, слой пластинок или трубочек. Такие грибы, подвергшиеся воздействию микопаразитов, в результате чего у них заросли спороносные трубочки или пластинки, в народе называются глухими грибами.
Микопаразиты — это в основном микроскопические грибы и лишь некоторые из них относятся к макроскопическим — шляпочным грибам из порядка пластинчатых (агариковых). Так, на шляпках сыроежек и некоторых млечников (скрипицы, белянки и др.) довольно часто можно встретить выросшие большими группами маленькие плодовые тела астерофоры паразитной с хрупкой шляпкой на тонкой ножке.
Есть грибы, паразитирующие на насекомых. В экологическую группу энтомофильных грибов в первую очередь входят грибы, использующие насекомых как питательный субстрат. Среди них полезны для человека грибы, паразитирующие на таких опасных для лесного хозяйства насекомых, как гусеница непарного шелкопряда, уничтожающая в отдельные годы целые лесные массивы. Поэтому, естественно, возникла идея использовать эти грибы-паразиты для борьбы с вредителями культурных растений. Длительные исследования дали положительные результаты.
Был найден гриб, боверия бассиана, очень перспективный для борьбы с целым рядом насекомых-вредителей. Он способен поражать свыше 70 видов насекомых, вызывая у них заболевание, называемое белой мускардиной. Из этих грибов был получен препарат боверин, используемый для борьбы с колорадским жуком, яблонной плодожоркой, свекловичным долгоносиком, клопом-черепашкой, вредящим посевам пшеницы, грушевым пилильщиком и др.
Метод борьбы с вредителями растений с помощью их природных естественных врагов называется биологическим методом и в последнее время находит все более широкое применение, заменяя химические средства борьбы. В настоящее время разработана технология промышленного получения боверина. На основе гриба пециломицеса розового получен еще один препарат — пециломин, применяемый для борьбы с вредителями плодовых кустарников, в том числе с широко распространенными смородинной и крыжовниковой огневками.
Грибы-микофилы облюбовали шляпочные грибы, на которых они растут и за счет которых питаются. Это в основном плесневые микроскопические грибы, но есть среди них и шляпочные, например астерофора паразитная
Грибы, заселяющие и использующие для питания очень специфические, зачастую неожиданные субстраты, образуют ограниченные экологические группы. Например, микофильные грибы поселяются как паразиты на своих собратьях грибах, причем среди них есть и микроскопические, и макроскопические. Особенно часто этих паразитов можно встретить на плодовых телах шляпочных грибов и трутовиков в виде белых, сероватых или другой окраски пленок, покрывающих поверхность шляпок, слой пластинок или трубочек. Такие грибы, подвергшиеся воздействию микопаразитов, в результате чего у них заросли спороносные трубочки или пластинки, в народе называются глухими грибами.
Микопаразиты — это в основном микроскопические грибы и лишь некоторые из них относятся к макроскопическим — шляпочным грибам из порядка пластинчатых (агариковых). Так, на шляпках сыроежек и некоторых млечников (скрипицы, белянки и др.) довольно часто можно встретить выросшие большими группами маленькие плодовые тела астерофоры паразитной с хрупкой шляпкой на тонкой ножке.
Есть грибы, паразитирующие на насекомых. В экологическую группу энтомофильных грибов в первую очередь входят грибы, использующие насекомых как питательный субстрат. Среди них полезны для человека грибы, паразитирующие на таких опасных для лесного хозяйства насекомых, как гусеница непарного шелкопряда, уничтожающая в отдельные годы целые лесные массивы. Поэтому, естественно, возникла идея использовать эти грибы-паразиты для борьбы с вредителями культурных растений. Длительные исследования дали положительные результаты.
Был найден гриб, боверия бассиана, очень перспективный для борьбы с целым рядом насекомых-вредителей. Он способен поражать свыше 70 видов насекомых, вызывая у них заболевание, называемое белой мускардиной. Из этих грибов был получен препарат боверин, используемый для борьбы с колорадским жуком, яблонной плодожоркой, свекловичным долгоносиком, клопом-черепашкой, вредящим посевам пшеницы, грушевым пилильщиком и др.
Метод борьбы с вредителями растений с помощью их природных естественных врагов называется биологическим методом и в последнее время находит все более широкое применение, заменяя химические средства борьбы. В настоящее время разработана технология промышленного получения боверина. На основе гриба пециломицеса розового получен еще один препарат — пециломин, применяемый для борьбы с вредителями плодовых кустарников, в том числе с широко распространенными смородинной и крыжовниковой огневками.
 Грибы-микофилы облюбовали шляпочные грибы, на которых они растут и за счет которых питаются. Это в основном плесневые микроскопические грибы, но есть среди них и шляпочные, например астерофора паразитная
Очень своеобразен и гриб кордицепс, паразитирующий в основном на личинках и куколках различных насекомых. Его грибница пронизывает личинку или куколку насекомого, мумифицируя ее. Затем из тела насекомого вырастают булавовидные плодовые тела гриба на длинных изогнутых ножках. Кордицепс — возбудительзаболевания шелковичного червя, которое серьезно отражается на его развитии, что приносит вред шелководству. Необычно приспособился к своему хозяину и гриб септобазидиум, паразитирующий на сосущих насекомых — червецах и щитовках, которые в свою очередь поселяются и питаются соками различных, чаще всего вечнозеленых растений.
В своеобразную цепочку складываются отношения трех организмов: гриба, который питается за счет насекомого, и насекомого, питающегося за счет растения. Механизм этого сопаразитизма следующий. Гриб в виде тонкой корочки покрывает стебли растения, но в ткани его грибница не проходит. В теле самого гриба, в особых камерах, находятся неподвижные щитовки или червецы, которые вонзают внутрь растения свои длинные хоботки и с помощью их питаются соками растения. Гриб в свою очередь заражает грибницей насекомое и питается за его счет, не убивая, однако, насекомое. Некоторые насекомые в камерах, не зараженные грибом, откладывают здесь свои яйца, из которых появляются подвижные личинки. Выйдя из камеры и проползая по поверхности гриба, личинки заражаются его липкими спорами, которые прорастают в гифы, внедряющиеся в тело личинки. Личинка уползает, унося в своем теле грибную инфекцию, а на новом месте превращается во взрослое неподвижное насекомое, присасываясь к растению. В это время находящаяся в ней грибница начинает расти; выходя наружу из тела насекомого и распространяясь вокруг него, образует тонкую корочку со спорами на поверхности. Таким образом, в рассматриваемом случае гриб тесно связан со своим хозяином не только в питании, но и в распространении. Необходимо отметить, что в камере гриба щитовки находят себе защиту не только от непогоды, но и от своих естественных врагов — различных птиц и других насекомых.
Паразитизм грибов на насекомых — это лишь одна сторона взаимоотношений этих организмов. Более сложные и интересные взаимоотношения существуют у некоторых тропических муравьев и термитов с грибами. Исследованиями установлено, что муравьи атта, обитающие в Южной Америке, а также некоторые термиты не только используют грибы как пищу, но и сами их разводят. Тропические муравьи на пережеванных ими листьях различных растений выращивают в муравейниках грибницу, а многие термиты для выращивания грибницы пользуются размельченной древесиной, которую размещают на стенках ходов в камерах термитников. Здесь образуется мягкое сероватое губчатое наслоение из грибницы, получившее название "грибные сады".
Грибы-микофилы облюбовали шляпочные грибы, на которых они растут и за счет которых питаются. Это в основном плесневые микроскопические грибы, но есть среди них и шляпочные, например астерофора паразитная
Очень своеобразен и гриб кордицепс, паразитирующий в основном на личинках и куколках различных насекомых. Его грибница пронизывает личинку или куколку насекомого, мумифицируя ее. Затем из тела насекомого вырастают булавовидные плодовые тела гриба на длинных изогнутых ножках. Кордицепс — возбудительзаболевания шелковичного червя, которое серьезно отражается на его развитии, что приносит вред шелководству. Необычно приспособился к своему хозяину и гриб септобазидиум, паразитирующий на сосущих насекомых — червецах и щитовках, которые в свою очередь поселяются и питаются соками различных, чаще всего вечнозеленых растений.
В своеобразную цепочку складываются отношения трех организмов: гриба, который питается за счет насекомого, и насекомого, питающегося за счет растения. Механизм этого сопаразитизма следующий. Гриб в виде тонкой корочки покрывает стебли растения, но в ткани его грибница не проходит. В теле самого гриба, в особых камерах, находятся неподвижные щитовки или червецы, которые вонзают внутрь растения свои длинные хоботки и с помощью их питаются соками растения. Гриб в свою очередь заражает грибницей насекомое и питается за его счет, не убивая, однако, насекомое. Некоторые насекомые в камерах, не зараженные грибом, откладывают здесь свои яйца, из которых появляются подвижные личинки. Выйдя из камеры и проползая по поверхности гриба, личинки заражаются его липкими спорами, которые прорастают в гифы, внедряющиеся в тело личинки. Личинка уползает, унося в своем теле грибную инфекцию, а на новом месте превращается во взрослое неподвижное насекомое, присасываясь к растению. В это время находящаяся в ней грибница начинает расти; выходя наружу из тела насекомого и распространяясь вокруг него, образует тонкую корочку со спорами на поверхности. Таким образом, в рассматриваемом случае гриб тесно связан со своим хозяином не только в питании, но и в распространении. Необходимо отметить, что в камере гриба щитовки находят себе защиту не только от непогоды, но и от своих естественных врагов — различных птиц и других насекомых.
Паразитизм грибов на насекомых — это лишь одна сторона взаимоотношений этих организмов. Более сложные и интересные взаимоотношения существуют у некоторых тропических муравьев и термитов с грибами. Исследованиями установлено, что муравьи атта, обитающие в Южной Америке, а также некоторые термиты не только используют грибы как пищу, но и сами их разводят. Тропические муравьи на пережеванных ими листьях различных растений выращивают в муравейниках грибницу, а многие термиты для выращивания грибницы пользуются размельченной древесиной, которую размещают на стенках ходов в камерах термитников. Здесь образуется мягкое сероватое губчатое наслоение из грибницы, получившее название "грибные сады".
 Грибы живущие на насекомых, или энтомофильные грибы, известны очень давно. Этот рисунок гриба кордицепс, паразитирующего на личинках и куколках различных насекомых, сделан братьями Тюлянь в 1863 г
Постоянно отрастающая грибница обгрызается насекомыми и служит им основной, а иногда и единственной достаточно калорийной пищей. На таких муравейниках вырастают грибы родов коллибия (денежка), зонтик, из гастеромицетов — подаксис пестичный, а на термитниках — гриб термитомицес, близкий к роду мухоморов. При образовании новых семей матка муравьев или термитов уносит во впадине слюнных желез немного грибницы, которая при образовании нового муравейника выбрасывается маткой на подготовленный рабочими муравьями субстрат из пережеванных листьев. На этом субстрате грибница начинает интенсивно развиваться и, таким образом, гриб распространяется. Распространение таких видов грибов в значительной степени связано с распространением самих муравьев и термитов; ареал грибов полностью зависит от того, насколько они могут существовать без муравьев или термитов. Так, если зонтики и коллибии встречаются довольно широко и растут вне муравейников, то термитомицес поселяется только на термитниках и, следовательно, его ареал, вероятно, совпадает с ареалом термитов. Известно более 30 видов термитов, использующих грибы для питания.
Некоторые обычные для нашей средней полосы шляпочные грибы-сапротрофы также поселяются на муравейниках или в непосредственной близости от них. Это шампиньон лесной, зонтик лохматый, колпак кольчатый, некоторые звездовики.
Несомненно, муравьи принимают участие и в распространении этих грибов, перенося их споры и микроскопические кусочки грибницы. Не совсем еще ясно, какую пользу из такого соседства извлекают сами муравьи. Не исключено, что они используют в пищу грибницу, которой прорастают стенки муравейника. Однако это предположение нуждается в экспериментальной проверке. Здесь существенно и то, что грибы и муравьи могут жить друг без друга.
Грибы живущие на насекомых, или энтомофильные грибы, известны очень давно. Этот рисунок гриба кордицепс, паразитирующего на личинках и куколках различных насекомых, сделан братьями Тюлянь в 1863 г
Постоянно отрастающая грибница обгрызается насекомыми и служит им основной, а иногда и единственной достаточно калорийной пищей. На таких муравейниках вырастают грибы родов коллибия (денежка), зонтик, из гастеромицетов — подаксис пестичный, а на термитниках — гриб термитомицес, близкий к роду мухоморов. При образовании новых семей матка муравьев или термитов уносит во впадине слюнных желез немного грибницы, которая при образовании нового муравейника выбрасывается маткой на подготовленный рабочими муравьями субстрат из пережеванных листьев. На этом субстрате грибница начинает интенсивно развиваться и, таким образом, гриб распространяется. Распространение таких видов грибов в значительной степени связано с распространением самих муравьев и термитов; ареал грибов полностью зависит от того, насколько они могут существовать без муравьев или термитов. Так, если зонтики и коллибии встречаются довольно широко и растут вне муравейников, то термитомицес поселяется только на термитниках и, следовательно, его ареал, вероятно, совпадает с ареалом термитов. Известно более 30 видов термитов, использующих грибы для питания.
Некоторые обычные для нашей средней полосы шляпочные грибы-сапротрофы также поселяются на муравейниках или в непосредственной близости от них. Это шампиньон лесной, зонтик лохматый, колпак кольчатый, некоторые звездовики.
Несомненно, муравьи принимают участие и в распространении этих грибов, перенося их споры и микроскопические кусочки грибницы. Не совсем еще ясно, какую пользу из такого соседства извлекают сами муравьи. Не исключено, что они используют в пищу грибницу, которой прорастают стенки муравейника. Однако это предположение нуждается в экспериментальной проверке. Здесь существенно и то, что грибы и муравьи могут жить друг без друга.
 Грибы-зонтики буквально прорастают через вершину и стенки муравейника, а грибница через весь муравейник. В чем причина такого своеобразного места обитания этих грибов, сказать пока трудно, но можно предположить, что здесь имеет значение особый состав почвы в муравейнике и около него
Сосуществование с грибами наблюдается и у таких насекомых, как древоточцы и короеды. В прогрызаемых этими насекомыми ходах развивается грибница, которая служит пищей для личинок. Гриб этот, относящийся к классу несовершенных, получил название амброзия (по-гречески — "пища богов"). Самки этих насекомых при откладке яиц переносят и кусочек грибницы, которая развивается на их экскрементах, постепенно разрастаясь по всем ходам насекомого. Развивающаяся личинка питается этим грибом.
Очень интересна и своеобразна экологическая группа грибов-хищников. Это почвенные микроскопические грибы, на грибнице которых образуются, как уже говорилось, особые ловчие кольца. Грибница улавливает этими кольцами живущих в почве микроскопических червей нематод, являющихся опасными вредителями сельскохозяйственных культур — хлебных злаков, картофеля, сахарной свеклы, различных овощей.
В настоящее время разработаны и проходят испытания методы биологической борьбы с нематодами с помощью хищных грибов, которые искусственно вносят в зараженную этими червями почву. Получены уже хорошие результаты при применении хищных грибов против галловой нематоды, особенно вредящей культуре огурцов в теплицах. Предпринимаются попытки использовать хищные грибы и против паразитических нематод человека и животных. Большой вклад в изучение хищных грибов и в разработку способов их полезного применения внес советский ученый Ф. Ф. Сопрунов.
В природе все организмы прямо или косвенно связаны друг с другом, поэтому естественно, что грибы находятся в определенном контакте и с позвоночными животными. Самый простой тип таких взаимоотношений — употребление животными грибов в пищу. Грибы охотно едят белки и даже заготавливают их на зиму. Грибами лакомятся ежи, едят их олени и многие другие животные, даже черепахи. Появляющиеся весной в степях шампиньоны, дождевики и особенно степные белые грибы составляют особенно лакомую пищу для степных черепах.
Грибы-зонтики буквально прорастают через вершину и стенки муравейника, а грибница через весь муравейник. В чем причина такого своеобразного места обитания этих грибов, сказать пока трудно, но можно предположить, что здесь имеет значение особый состав почвы в муравейнике и около него
Сосуществование с грибами наблюдается и у таких насекомых, как древоточцы и короеды. В прогрызаемых этими насекомыми ходах развивается грибница, которая служит пищей для личинок. Гриб этот, относящийся к классу несовершенных, получил название амброзия (по-гречески — "пища богов"). Самки этих насекомых при откладке яиц переносят и кусочек грибницы, которая развивается на их экскрементах, постепенно разрастаясь по всем ходам насекомого. Развивающаяся личинка питается этим грибом.
Очень интересна и своеобразна экологическая группа грибов-хищников. Это почвенные микроскопические грибы, на грибнице которых образуются, как уже говорилось, особые ловчие кольца. Грибница улавливает этими кольцами живущих в почве микроскопических червей нематод, являющихся опасными вредителями сельскохозяйственных культур — хлебных злаков, картофеля, сахарной свеклы, различных овощей.
В настоящее время разработаны и проходят испытания методы биологической борьбы с нематодами с помощью хищных грибов, которые искусственно вносят в зараженную этими червями почву. Получены уже хорошие результаты при применении хищных грибов против галловой нематоды, особенно вредящей культуре огурцов в теплицах. Предпринимаются попытки использовать хищные грибы и против паразитических нематод человека и животных. Большой вклад в изучение хищных грибов и в разработку способов их полезного применения внес советский ученый Ф. Ф. Сопрунов.
В природе все организмы прямо или косвенно связаны друг с другом, поэтому естественно, что грибы находятся в определенном контакте и с позвоночными животными. Самый простой тип таких взаимоотношений — употребление животными грибов в пищу. Грибы охотно едят белки и даже заготавливают их на зиму. Грибами лакомятся ежи, едят их олени и многие другие животные, даже черепахи. Появляющиеся весной в степях шампиньоны, дождевики и особенно степные белые грибы составляют особенно лакомую пищу для степных черепах.
 Навозник в стадии автолиза
Питаясь грибами, разнося при этом их плодовые тела и особенно споры, которые обычно проходят неповрежденными через кишечный тракт животных и выделяются с экскрементами, животные таким образом участвуют в распространении грибов. Некоторые грибы оказались и более тесно связаны с позвоночными животными: экскременты их — основной субстрат для грибов. Такие грибы составляют особую экологическую группу копрофильных грибов (от греческого слова "копрос" — навоз). Здесь, как и на древесине, одни грибы в определенной последовательности сменяются другими. К копрофильным относятся микроскопические грибы из класса зигомицетов и сумчатых и шляпочные грибы из класса базидиальных, в основном из семейства навозниковых. Все они растут на субстрате, богатом органическими веществами, в частности многие виды рода навозник — навозники белый и серый. Эти виды распространены и в районах интенсивной деятельности человека, связанной с обогащением почвы органическими веществами. Грибы как бы идут вслед за человеком, поселяясь возле ферм, городских свалок, на хорошо удобренной почве парков и скверов, расширяя таким образом свой ареал и становясь космополитами. Особенность спор копрофильных грибов — удивительная устойчивость к воздействию ферментов пищеварительного тракта животного.
Есть также грибы — паразиты человека и животных, дрожжевые грибы симбиотрофы, обитающие в кишечнике человека и животных.
Скорее по месту обитания, чем по субстрату, выделяют экологическую группу водных грибов. Они живут в самых разнообразных водоемах: океанах и морях, реках и озерах, болотах и даже в термальных источниках.
Вода является древнейшей средой обитания грибов. Поэтому именно в водоемах до сих пор сохранились наиболее древние группы низших грибов из класса хитридиевых и оомицетов, в основном это внутриклеточные паразиты водных беспозвоночных животных (коловраток и др.) или водорослей. В сложном цикле развития этих грибов сохранились подвижные стадии, связанные с размножением. Чаще всего это клетка со жгутиками — зооспора, обеспечивающая наиболее легкий способ расселения в воде. Зооспоры очень похожи на флагеллят — древнейших предков грибов. Присутствие у грибов зооспор в какой-то степени подтверждает гипотезу происхождения грибов от этих древнейших обитателей нашей планеты и древность самих этих групп грибов — хитридиевых и оомицетов, которые составляют значительную часть водных грибов. Другая часть — водные грибы сапротрофы из классов сумчатых и несовершенных, поселяющиеся на гниющих в воде листьях и других растительных остатках. Будучи гетеротрофными организмами, эти грибы, которые произошли, вероятно, от обитающих на суше, играют большую роль в общем круговороте веществ в водоемах, разлагая сложные органические вещества, особенно растительного происхождения, и способствуя биологическому самоочищению водоемов. Представьте себе лесное озеро или речку в середине осени — в это время их поверхность покрыта опавшими листьями. Но проходит несколько дней, и водоемы очищаются, поскольку листья, намокнув, опускаются на дно, где их без промедления заселяют водные грибы, которые постепенно, на протяжении следующих весны и лета полностью разложат эти листья, очистив водоем, Некоторые грибы, в основном, из класса несовершенных, вместе с бактериями могут разрушать нефтепродукты, ядохимикаты и другие вещества, содержащиеся в сточных водах.
У водных грибов, в основном сапротрофов, есть приспособления, облегчающие им не только существование в воде, но и распространение. В частности, споры некоторых из них разветвлены и часто несут четыре лучеобразных отростка, выходящих из одной точки. Такая форма спор затрудняет их оседание на дно водоема, позволяет длительное время находиться как бы во взвешенном состоянии в толще воды, что значительно увеличивает шансы их распространения токами воды.
И все же основное место обитания грибов-сапротрофов — почва, в которой находится огромное, даже трудно поддающееся учету количество спор и грибниц. Анализами установлено, что в среднем в 1 г подзолистой почвы содержится до 80 тыс. спор и отдельных микроскопических кусочков грибницы, которые могут дать жизнь новому грибу. В более богатых органическими веществами перегнойных почвах количество спор и мицелия еще больше. Нетрудно себе представить, какую огромную роль в почвообразовании играют грибы. Находясь в почве в громадных количествах, они беспрерывно разрушают содержащиеся в ней растительные остатки, используя их составные части как для построения своего собственного тела, так и для обогащения почвы.
Навозник в стадии автолиза
Питаясь грибами, разнося при этом их плодовые тела и особенно споры, которые обычно проходят неповрежденными через кишечный тракт животных и выделяются с экскрементами, животные таким образом участвуют в распространении грибов. Некоторые грибы оказались и более тесно связаны с позвоночными животными: экскременты их — основной субстрат для грибов. Такие грибы составляют особую экологическую группу копрофильных грибов (от греческого слова "копрос" — навоз). Здесь, как и на древесине, одни грибы в определенной последовательности сменяются другими. К копрофильным относятся микроскопические грибы из класса зигомицетов и сумчатых и шляпочные грибы из класса базидиальных, в основном из семейства навозниковых. Все они растут на субстрате, богатом органическими веществами, в частности многие виды рода навозник — навозники белый и серый. Эти виды распространены и в районах интенсивной деятельности человека, связанной с обогащением почвы органическими веществами. Грибы как бы идут вслед за человеком, поселяясь возле ферм, городских свалок, на хорошо удобренной почве парков и скверов, расширяя таким образом свой ареал и становясь космополитами. Особенность спор копрофильных грибов — удивительная устойчивость к воздействию ферментов пищеварительного тракта животного.
Есть также грибы — паразиты человека и животных, дрожжевые грибы симбиотрофы, обитающие в кишечнике человека и животных.
Скорее по месту обитания, чем по субстрату, выделяют экологическую группу водных грибов. Они живут в самых разнообразных водоемах: океанах и морях, реках и озерах, болотах и даже в термальных источниках.
Вода является древнейшей средой обитания грибов. Поэтому именно в водоемах до сих пор сохранились наиболее древние группы низших грибов из класса хитридиевых и оомицетов, в основном это внутриклеточные паразиты водных беспозвоночных животных (коловраток и др.) или водорослей. В сложном цикле развития этих грибов сохранились подвижные стадии, связанные с размножением. Чаще всего это клетка со жгутиками — зооспора, обеспечивающая наиболее легкий способ расселения в воде. Зооспоры очень похожи на флагеллят — древнейших предков грибов. Присутствие у грибов зооспор в какой-то степени подтверждает гипотезу происхождения грибов от этих древнейших обитателей нашей планеты и древность самих этих групп грибов — хитридиевых и оомицетов, которые составляют значительную часть водных грибов. Другая часть — водные грибы сапротрофы из классов сумчатых и несовершенных, поселяющиеся на гниющих в воде листьях и других растительных остатках. Будучи гетеротрофными организмами, эти грибы, которые произошли, вероятно, от обитающих на суше, играют большую роль в общем круговороте веществ в водоемах, разлагая сложные органические вещества, особенно растительного происхождения, и способствуя биологическому самоочищению водоемов. Представьте себе лесное озеро или речку в середине осени — в это время их поверхность покрыта опавшими листьями. Но проходит несколько дней, и водоемы очищаются, поскольку листья, намокнув, опускаются на дно, где их без промедления заселяют водные грибы, которые постепенно, на протяжении следующих весны и лета полностью разложат эти листья, очистив водоем, Некоторые грибы, в основном, из класса несовершенных, вместе с бактериями могут разрушать нефтепродукты, ядохимикаты и другие вещества, содержащиеся в сточных водах.
У водных грибов, в основном сапротрофов, есть приспособления, облегчающие им не только существование в воде, но и распространение. В частности, споры некоторых из них разветвлены и часто несут четыре лучеобразных отростка, выходящих из одной точки. Такая форма спор затрудняет их оседание на дно водоема, позволяет длительное время находиться как бы во взвешенном состоянии в толще воды, что значительно увеличивает шансы их распространения токами воды.
И все же основное место обитания грибов-сапротрофов — почва, в которой находится огромное, даже трудно поддающееся учету количество спор и грибниц. Анализами установлено, что в среднем в 1 г подзолистой почвы содержится до 80 тыс. спор и отдельных микроскопических кусочков грибницы, которые могут дать жизнь новому грибу. В более богатых органическими веществами перегнойных почвах количество спор и мицелия еще больше. Нетрудно себе представить, какую огромную роль в почвообразовании играют грибы. Находясь в почве в громадных количествах, они беспрерывно разрушают содержащиеся в ней растительные остатки, используя их составные части как для построения своего собственного тела, так и для обогащения почвы.
 Отростки спор водных грибов могут играть роль якоря, позволяющего споре зацепиться за подходящий субстракт: такие споры не так-то легко проглотить кому-нибудь из микроскопических беспозвоночных животных
Процессы распада сложных органических веществ биологического происхождения и в первую очередь таких, как клетчатка и лигнин, представляют собой одну из важнейших проблем биологии и почвоведения, поскольку именно эти вещества являются главными составными растительного опада и древесины и от их разложения собственно и зависит круговорот соединений углерода в природе.
Подсчитано, что на земном шаре ежегодно синтезируется от 50 до 100 млрд. т органического вещества, большую массу которого составляют соединения растительного происхождения. Основную работу по разложению этих отмерших растений выполняют грибы — активные разрушители целлюлозы и лигнина.
Таким образом, грибы играют в природе чрезвычайно важную и весьма своеобразную роль. Разлагая растительные остатки, они активно участвуют в вечном круговороте веществ. Из этой их особенности вытекает и их роль в биогеоценозах — сложных природных комплексах живых организмов и неживых компонентов, находящихся в динамическом взаимодействии. В биогеоценозах грибы, с одной стороны, вызывают разложение органических веществ, с другой — сами служат источниками питания для других организмов — бактерий, беспозвоночных и позвоночных; имеется и третий симбиотический аспект взаимоотношений грибов с растительными компонентами биогеоценоза — образование микоризы.
Можно отметить и еще более сложные связи некоторых грибов с компонентами биогеоценоза. Так, многие почвенные сапротрофы-макромицеты находятся в тесной связи с микрофлорой, потому что и бактерии и микроскопические грибы подготавливают почву для макромицетов. Дело в том, что выделяемые микроскопическими грибами и бактериями вещества являются совершенно необходимыми для плодоношения многих шляпочных грибов. Установлено, что шампиньоны и некоторые другие почвенные сапротрофы развивают грибницу, но не образуют плодовых тел на стерильной почве, т. е. такой, где отсутствуют определенные бактерии и микроскопические грибы. Чем это вызвано и почему наличие определенных микроскопических организмов является обязательным условием для плодоношения шампиньонов, еще не ясно. Проблема эта настолько интересна и важна для искусственного разведения грибов, что сейчас ею занимаются многие микологи. Этот пример показывает, как важны все компоненты биогеоценоза для нормального функционирования как всего биогеоценоза, так и его отдельных компонентов.
Отростки спор водных грибов могут играть роль якоря, позволяющего споре зацепиться за подходящий субстракт: такие споры не так-то легко проглотить кому-нибудь из микроскопических беспозвоночных животных
Процессы распада сложных органических веществ биологического происхождения и в первую очередь таких, как клетчатка и лигнин, представляют собой одну из важнейших проблем биологии и почвоведения, поскольку именно эти вещества являются главными составными растительного опада и древесины и от их разложения собственно и зависит круговорот соединений углерода в природе.
Подсчитано, что на земном шаре ежегодно синтезируется от 50 до 100 млрд. т органического вещества, большую массу которого составляют соединения растительного происхождения. Основную работу по разложению этих отмерших растений выполняют грибы — активные разрушители целлюлозы и лигнина.
Таким образом, грибы играют в природе чрезвычайно важную и весьма своеобразную роль. Разлагая растительные остатки, они активно участвуют в вечном круговороте веществ. Из этой их особенности вытекает и их роль в биогеоценозах — сложных природных комплексах живых организмов и неживых компонентов, находящихся в динамическом взаимодействии. В биогеоценозах грибы, с одной стороны, вызывают разложение органических веществ, с другой — сами служат источниками питания для других организмов — бактерий, беспозвоночных и позвоночных; имеется и третий симбиотический аспект взаимоотношений грибов с растительными компонентами биогеоценоза — образование микоризы.
Можно отметить и еще более сложные связи некоторых грибов с компонентами биогеоценоза. Так, многие почвенные сапротрофы-макромицеты находятся в тесной связи с микрофлорой, потому что и бактерии и микроскопические грибы подготавливают почву для макромицетов. Дело в том, что выделяемые микроскопическими грибами и бактериями вещества являются совершенно необходимыми для плодоношения многих шляпочных грибов. Установлено, что шампиньоны и некоторые другие почвенные сапротрофы развивают грибницу, но не образуют плодовых тел на стерильной почве, т. е. такой, где отсутствуют определенные бактерии и микроскопические грибы. Чем это вызвано и почему наличие определенных микроскопических организмов является обязательным условием для плодоношения шампиньонов, еще не ясно. Проблема эта настолько интересна и важна для искусственного разведения грибов, что сейчас ею занимаются многие микологи. Этот пример показывает, как важны все компоненты биогеоценоза для нормального функционирования как всего биогеоценоза, так и его отдельных компонентов.
 Эти обычные для нас грибы появились в необычном месте (на огороде) через несколько дней после уборки картофеля. Грибница их росла в почве и, возможно, даже входила в контакт с корнями картофеля
Итак, на расселение грибов на земном шаре могут оказывать влияние многочисленные взаимодействующие между собой факторы: субстрат, климат, наличие симбионтных растений-партнеров, хозяйственная деятельность человека и многое другое.
Эти обычные для нас грибы появились в необычном месте (на огороде) через несколько дней после уборки картофеля. Грибница их росла в почве и, возможно, даже входила в контакт с корнями картофеля
Итак, на расселение грибов на земном шаре могут оказывать влияние многочисленные взаимодействующие между собой факторы: субстрат, климат, наличие симбионтных растений-партнеров, хозяйственная деятельность человека и многое другое.
Грибы различных физико-географических зон
Микогеография — относительно молодая ветвь микологии. Здесь еще идет в основном накопление сведений и материала, который в будущем позволит выявить общие закономерности в расселении грибов на нашей планете. Пока можно сформулировать лишь отдельные ее положения Во-первых, распределение шляпочных грибов, трутовиков и многих микроскопических грибов в значительной степени связано с флорой высших цветковых растений. Во-вторых, в условиях холодного и умеренного климатов Северного полушария на одной и той же значительной территории количество семенных растений выше, чем количество видов грибов. Однако для небольших территорий эта закономерность не прослеживается, и иногда количество видов грибов может превышать число семенных растений, но при расширении наблюдаемой территории эта разница постепенно сглаживается. Можно также отметить, что грибы занимают более обширные территории, чем высшие растения, и ареалам шляпочных грибов обычно соответствуют ареалы не видов, а родов семенных растений. Исследованиями установлено, что на территории СССР шляпочные грибы распространены очень широко: от крайних пределов растительности на островах Северного Ледовитого океана и вершинах гор в непосредственной близости с ледниками до субтропических лесов Закавказья и пустынь Казахстана- и Средней Азии. Анализ видов шляпочных грибов, растущих в разных физико-географических зонах нашей страны (арктических пустынях, тундре, лесной, степной и пустынной зонах), показал, что каждая зона характеризуется своим специфическим набором видов. Это не значит, что в разных зонах не будут встречаться одни и те же виды грибов, но для каждой зоны можно выделить свой специфический вид или специфический комплекс видов. Например, те или иные микоризные грибы будут присутствовать в лесной зоне в зависимости от наличия различных типов леса. Для леса характерны, например, рыжики, чернушки и др., которые не растут в степи. В степной зоне распространены гастеромицеты — тарелочница белая, тулостома зимняя, головач белый, сетчатоголовник вытянутый и др., характерны и шляпочные грибы — степной белый, а также многочисленные виды грибов-зонтиков, шампиньонов, которые хотя и встречаются в лесной зоне, на полях, опушках и лугах, но растут там рассеянно, на отдельных участках, единичными экземплярами, не составляя основного комплекса видов. Для пустынь характерны баттарея веселковидная, феллоринии геркулесовая и шишковатая, пустынный шампиньон Бернара, монтанея песчаная. Заметное изменение видового состава грибов происходит в широтном направлении — с севера на юг, что свидетельствует о большой чувствительности грибов к даже небольшим изменениям температуры и влажности. В меридиональном направлении — с запада на восток, т. е. практически в пределах той же физико-географической зоны, эти изменения менее значительны и не столь резки. Изучение распространения шляпочных грибов позволяет выделить в настоящее время основные типы их ареалов: • европейский, куда относятся, например, цезарский гриб, опенок весенний, рядовка оранжевая, микофил астерофора паразитная, растущая на сыроежках и млечниках; • голарктический, или циркумполярный, куда входят грибы, растущие в умеренном поясе (Европы, Азии и Северной Америки), — подосиновики, подберезовики, перечный гриб, дубовик крапчатый, свинушка толстая, гриб-зонтик лохматый и др.; • европейско-американо-дальневосточный, куда относятся виды, растущие в областях широколиственных лесов, например вешенка дубовая; • европейско-азиатский, или палеарктический, для видов шляпочных грибов обычных в зонах лесов умеренного пояса (бореальных видов), но отсутствующих в лесной зоне Северной Америки, — сыроежка цельная, ядовитая волоконница Патуйяра, зонтик розовый и др.; • европейско-североамериканский, для которого характерны сатанинский гриб, обабок серый, близкий к подберезовику, но растущий под грабами, и др. Примерно 70% шляпочных грибов Северной Америки имеют этот тип ареала, в то же время примерно 70% шляпочных грибов Дальнего Востока (Приморья) имеют американо-дальневосточный тип ареала, например, крупный съедобный гриб — катателязма вздутая, которую на Дальнем Востоке называют сахалинским шампиньоном. Предполагают, что возникновение трех последних ареалов связано с оледенением, происшедшим в четвертичном периоде кайнозойской эры, около 2,5 млн. лет назад. В результате этого оледенения голарктический ареал широколиственных и хвойно-широколиственных лесов третичного периода оказался разделенным на три части: европейскую, американскую и дальневосточную. Эти типы лесов до сих пор сохранились в Европе, Северной Америке (юго-восток США) и в Азии (на юге Дальнего Востока). Кроме того, под влиянием различных климатических условий часть когда-то общих для всего голарктического ареала древесных пород вымерла и в каких-то частях ареала возникли в процессе эволюции новые древесные породы. Соответственно с этим сохранились или исчезли отдельные виды шляпочных грибов, связанных с этими породами. Отсюда и возникли названные сочетания ареалов, занятых отдельными видами шляпочных грибов. Из других типов ареалов можно назвать европейско-азиатско-американо-аветралийский, характерный для таких ксилотрофов, как рядовка желто-красная или опенок летний, или евразиатско — североамерикано — африканский, характерный для белого гриба. Палеотропический ареал имеют грибы, растущие в тропической Африке и тропическом поясе Азии. Это популярный в Индии съедобный гриб калоцибе индийский, а также съедобный термитомицес, растущий на термитниках и широко употребляемый в пищу населением Бирмы. Неотропический ареал занимают грибы, растущие в Центральной Америке и тропическом поясе Южной Америки, например псилоцибе мексиканский. Довольно узкими являются такие типы ареалов, как азиатский, с видами, приуроченными к лесам Сибири, североамериканский и австралийский. Очень интересны два противоположных по своему содержанию ареала — космополитный и эндемичный. Широко распространенные по всем континентам земного шара космополитные виды составляют около 5% всех шляпочных грибов. Среди них преобладают ксилотрофы, живущие на древесине (опенок осенний и вешенка устричная), а также виды, растущие на открытых пространствах (шампиньоны обыкновенный и полевой, навозники белый и серый, гриб-зонтик пестрый). Лесных видов здесь меньше: поплавок, красный мухомор, дождевик обыкновенный и некоторые другие, растущие на лесной подстилке или вступающие в микоризный симбиоз с самыми различными древесными породами. Как уже упоминалось, эндемичный ареал имеют грибы, приуроченные к какой-либо ограниченной, часто очень небольшой территории. Например, только в Приморье растет мухомор цезариевидный, груздь пихтовый, ламптеромицес японский, или светящийся гриб. Это один из немногих сильно светящихся шляпочных грибов, пластинки которого излучают белый свет при температуре 10... 15°С. Это крупный гриб с розовато-охристой шляпкой и с боковой или эксцентричной ножкой. Растет он на стволах широколиственных пород, особенно липы и бука, а также на валежнике и имеет приятный запах, хотя и является ядовитым грибом. Для Украины отмечены эндемичные виды шампиньонов — мухоморовидный и длинноножковый. На территории Казахстана найдено несколько эндемичных видов порховок и тулостом из группы гастеромицетов. Известны эндемичные виды сыроежек и млечников из Африки (о. Мадагаскар) — млечник панданусовый, растущий на гнилушках панданусов, сыроежки укореняющаяся и кольцевая — реликтовые виды, относящиеся к числу древнейших из ныне живущих агариковых грибов: их возраст несколько десятков миллионов лет. Сохранились эти грибы с далеких геологических периодов на относительно небольших территориях, где климатические условия не претерпели значительных изменений. В других местах в связи с изменениями климата эти виды вымерли. Таким образом, реликтовые виды грибов часто имеют эндемичный ареал. Однако точное определение эндемичного ареала того или иного вида зависит от полноты исследования территорий, и пока остаются малоисследованные, даже не исследованные по флоре грибов территории, выделять эндемичные виды грибов и растений надо крайне осторожно. Грибы степей и пустынь: 1 — тулостома зимняя; 2 — шампиньон крупноспоровый; 3 — тарелочница белая; 4- вешенка степная, или 'степной белый гриб'; 5 — шампиньон таблитчатый; 6 — галеропсис пустынный; 7 — монтанея песчаная; 8 — головач пузыревидный
Перечисленными типами ареалы грибов, однако, не ограничиваются. Ряд микологов выделяют еще европейско-африканский, евразиатско-африканский, европейско-американо-африканский, евразиатско-американо-австралийский и др. В настоящее время исчерпывающими данными о распространении грибов на земном шаре микология еще не располагает. Микофлоры многих областей, а часто и целых континентов, например Австралии и Южной Америки, особенно ее центральной части, изучены недостаточно. Поэтому выделение типов ареалов и отнесение того или иного вида гриба к определенному ареалу носит предварительный характер и исследования в этом направлении продолжаются.
Обобщая все известные сведения о распросранении шляпочных грибов, можно выделить следующие основные положения микогеографии:
• а) грибам присущи обширные ареалы, часто охватывающие различные климатические зоны;
• б) распространение грибов контролируется преимущественно распространением субстратов;
• в) ареалам шляпочных грибов обычно соответствуют ареалы не видов, а родов семейных растений, т. е. грибы расселены более широко, чем растения.
Можно, однако, предположить, что причина такого широкого расселения шляпочных грибов заключается в их биологической особенности, а именно в строении и жизни их вегетативного тела — грибницы, которая всегда находится внутри субстрата (в почве, древесине) и, таким образом, будучи защищена им, относительно мало подвергается вредным воздействиям неблагоприятных климатических условий.
Дальнейшее изучение географического распространения грибов, создание более унифицированной классификации типов ареалов дадут возможность установить закономерности возникновения и распространения той или иной группы грибов, их приуроченность к определенной территории и пути миграции.
Грибы степей и пустынь: 1 — тулостома зимняя; 2 — шампиньон крупноспоровый; 3 — тарелочница белая; 4- вешенка степная, или 'степной белый гриб'; 5 — шампиньон таблитчатый; 6 — галеропсис пустынный; 7 — монтанея песчаная; 8 — головач пузыревидный
Перечисленными типами ареалы грибов, однако, не ограничиваются. Ряд микологов выделяют еще европейско-африканский, евразиатско-африканский, европейско-американо-африканский, евразиатско-американо-австралийский и др. В настоящее время исчерпывающими данными о распространении грибов на земном шаре микология еще не располагает. Микофлоры многих областей, а часто и целых континентов, например Австралии и Южной Америки, особенно ее центральной части, изучены недостаточно. Поэтому выделение типов ареалов и отнесение того или иного вида гриба к определенному ареалу носит предварительный характер и исследования в этом направлении продолжаются.
Обобщая все известные сведения о распросранении шляпочных грибов, можно выделить следующие основные положения микогеографии:
• а) грибам присущи обширные ареалы, часто охватывающие различные климатические зоны;
• б) распространение грибов контролируется преимущественно распространением субстратов;
• в) ареалам шляпочных грибов обычно соответствуют ареалы не видов, а родов семейных растений, т. е. грибы расселены более широко, чем растения.
Можно, однако, предположить, что причина такого широкого расселения шляпочных грибов заключается в их биологической особенности, а именно в строении и жизни их вегетативного тела — грибницы, которая всегда находится внутри субстрата (в почве, древесине) и, таким образом, будучи защищена им, относительно мало подвергается вредным воздействиям неблагоприятных климатических условий.
Дальнейшее изучение географического распространения грибов, создание более унифицированной классификации типов ареалов дадут возможность установить закономерности возникновения и распространения той или иной группы грибов, их приуроченность к определенной территории и пути миграции.
 Мутинус Равенеля родом из Северной Америки. В Западной Европе он был обнаружен в 1942 г., а у нас в 50-е годы в Риге и ее окрестностях; в 80-е годы его уже находят под Москвой, где он хорошо акклиматизировался и растет большими группами во дворах, на газонах и грядках среди овощей и цветов
Здесь интересно остановиться на нескольких фактах появления на территории СССР новых видов грибов, занесенных, по-видимому, с посадочным материалом каких-либо сельскохозяйственных или декоративных растений. Один из них — мутинус Равенеля — впервые был обнаружен в 50-е годы под Ригой, хотя родина его Северная Америка. В 60-е и 70-е годы его все чаще находили и в самой Риге, и в ее окрестностях, и в других местах Латвии. Однако до 1978 г. этот гриб принимали за встречающийся на территории нашей страны мутинус собачий. Более детальное изучение показало, что это совсем другой, новый для нашей страны гриб. Мутинус Равенеля отличается от мутинуса собачьего тем, что его губчатая ножка (рецептакул) в верхней части ярко-малинового цвета, а в нижней беловато-розового. У мутинуса собачьего рецептакул белый или желтовато-оранжевый. У обоих грибов на вершине маленькая серовато-зеленая расплывающаяся шапочка, издающая сильный неприятный запах.
В 1976 г. в Свердловской обл. в огуречных теплицах впервые у нас в стране был обнаружен очень экзотичный гриб лизурус Грандера, родина которого о. Шри-Ланка и Индия. Как и мутинус Равенеля, этот гриб — родственник нашей распространенной веселки обыкновенной. В 1981 г. он был обнаружен в Архангельске, а в 1982 г. в г. Ржеве Калининской обл. Пока его находят только в огуречных теплицах и парниках, однако при подходящих условиях он может акклиматизироваться и распространиться в естественных условиях, как это произошло с тропическими грибами решеточником красным и антурусом яванским, занесенными в нашу страну в 30-40-е годы и ставшими постоянными, хотя и редкими обитателями нашей субтропической зоны.
Мутинус Равенеля родом из Северной Америки. В Западной Европе он был обнаружен в 1942 г., а у нас в 50-е годы в Риге и ее окрестностях; в 80-е годы его уже находят под Москвой, где он хорошо акклиматизировался и растет большими группами во дворах, на газонах и грядках среди овощей и цветов
Здесь интересно остановиться на нескольких фактах появления на территории СССР новых видов грибов, занесенных, по-видимому, с посадочным материалом каких-либо сельскохозяйственных или декоративных растений. Один из них — мутинус Равенеля — впервые был обнаружен в 50-е годы под Ригой, хотя родина его Северная Америка. В 60-е и 70-е годы его все чаще находили и в самой Риге, и в ее окрестностях, и в других местах Латвии. Однако до 1978 г. этот гриб принимали за встречающийся на территории нашей страны мутинус собачий. Более детальное изучение показало, что это совсем другой, новый для нашей страны гриб. Мутинус Равенеля отличается от мутинуса собачьего тем, что его губчатая ножка (рецептакул) в верхней части ярко-малинового цвета, а в нижней беловато-розового. У мутинуса собачьего рецептакул белый или желтовато-оранжевый. У обоих грибов на вершине маленькая серовато-зеленая расплывающаяся шапочка, издающая сильный неприятный запах.
В 1976 г. в Свердловской обл. в огуречных теплицах впервые у нас в стране был обнаружен очень экзотичный гриб лизурус Грандера, родина которого о. Шри-Ланка и Индия. Как и мутинус Равенеля, этот гриб — родственник нашей распространенной веселки обыкновенной. В 1981 г. он был обнаружен в Архангельске, а в 1982 г. в г. Ржеве Калининской обл. Пока его находят только в огуречных теплицах и парниках, однако при подходящих условиях он может акклиматизироваться и распространиться в естественных условиях, как это произошло с тропическими грибами решеточником красным и антурусом яванским, занесенными в нашу страну в 30-40-е годы и ставшими постоянными, хотя и редкими обитателями нашей субтропической зоны.
 Экзотический гость из Шри-Ланки — лизурус Грандера
Вопросы, связанные с распространением грибов, приспособляемостью их к различным, часто совершенно неожиданным условиям, с путями и способами их миграции, интересуют не только микологов, но и врачей, работников сельского хозяйства и др. В СССР проделана большая работа по изучению миграции фитопатогенных грибов, выяснению ее закономерностей, что является основой предупреждения болезней сельскохозяйственных растений. Эти вопросы изучены еще недостаточно и, как отмечалось в 1978 г. на VII Конгрессе европейских микологов в Будапеште, именно они должны в ближайшее время оказаться в центре внимания микологов. В настоящее время идет разработка подробной карты распространения грибов на земном шаре. Составлением ее занимаются микологи всех континентов, и советские ученые принимают в этой работе самое активное участие.
Экзотический гость из Шри-Ланки — лизурус Грандера
Вопросы, связанные с распространением грибов, приспособляемостью их к различным, часто совершенно неожиданным условиям, с путями и способами их миграции, интересуют не только микологов, но и врачей, работников сельского хозяйства и др. В СССР проделана большая работа по изучению миграции фитопатогенных грибов, выяснению ее закономерностей, что является основой предупреждения болезней сельскохозяйственных растений. Эти вопросы изучены еще недостаточно и, как отмечалось в 1978 г. на VII Конгрессе европейских микологов в Будапеште, именно они должны в ближайшее время оказаться в центре внимания микологов. В настоящее время идет разработка подробной карты распространения грибов на земном шаре. Составлением ее занимаются микологи всех континентов, и советские ученые принимают в этой работе самое активное участие.
Грибы и почва
Что такое почвенные грибы
 Любая почва насыщена микроскопическими грибами. Колония одного из них
Среди живых организмов, обитающих в почве, не последнее место занимают грибы. Грибница пронизывает и оплетает все почвенные частицы. Иногда можно видеть ее нити простым глазом, например, когда множество их объединяется по всей длине, образуя светлые тяжи или шнуры, тянущиеся иногда на большие расстояния, т. е. те светлые тяжи, которые мы видим отходящими от основания плодовых тел шляпочных грибов, когда их собираем. Во влажную погоду грибница иногда появляется и на поверхности земли, на лесных тропинках, часто в виде больших скоплений.
Тот слой почвы, который находится в лесу под свежим опадом и уже тронут разложением, бывает буквально пронизан грибными гифами, покрыт пушистым нитевидным налетом, видимым невооруженным глазом.
Если взять небольшую навеску любой почвы, разболтать ее тщательно в небольшом количестве стерильной воды и поместить несколько капель такой болтушки на поверхность питательной среды, на ней вскоре появятся колонии различных грибов. При высеве одних почв колонии будут более или менее однородны по окраске, скорости роста, строению, а при высеве других вся поверхность чашки со средой оказывается покрытой колониями грибов самых разных цветов и строения, что свидетельствует о разнообразии видов, населяющих данную почву. На поверхности чашки колонии образуются или из обрывков грибницы, или из спор микроскопических грибов, присутствующих в почве.
Любая почва насыщена микроскопическими грибами. Колония одного из них
Среди живых организмов, обитающих в почве, не последнее место занимают грибы. Грибница пронизывает и оплетает все почвенные частицы. Иногда можно видеть ее нити простым глазом, например, когда множество их объединяется по всей длине, образуя светлые тяжи или шнуры, тянущиеся иногда на большие расстояния, т. е. те светлые тяжи, которые мы видим отходящими от основания плодовых тел шляпочных грибов, когда их собираем. Во влажную погоду грибница иногда появляется и на поверхности земли, на лесных тропинках, часто в виде больших скоплений.
Тот слой почвы, который находится в лесу под свежим опадом и уже тронут разложением, бывает буквально пронизан грибными гифами, покрыт пушистым нитевидным налетом, видимым невооруженным глазом.
Если взять небольшую навеску любой почвы, разболтать ее тщательно в небольшом количестве стерильной воды и поместить несколько капель такой болтушки на поверхность питательной среды, на ней вскоре появятся колонии различных грибов. При высеве одних почв колонии будут более или менее однородны по окраске, скорости роста, строению, а при высеве других вся поверхность чашки со средой оказывается покрытой колониями грибов самых разных цветов и строения, что свидетельствует о разнообразии видов, населяющих данную почву. На поверхности чашки колонии образуются или из обрывков грибницы, или из спор микроскопических грибов, присутствующих в почве.
 Тяжи мицелия на поверхности почвы
Известно, что древесные остатки, изделия из различных материалов, погруженные в почву целиком или частично, постепенно разрушаются. При извлечении их из почвы можно обнаружить грибные налеты или колонии, иногда довольно разнообразные. Подземные части растений тоже часто становятся объектами нападения грибов. Все это говорит о том, что источник этой заразы — почвенные грибы. Не будет ошибкой сказать, что плесневение пищевых продуктов, разрушения различных материалов на поверхности земли тоже вызываются почвенными грибами, споры которых попадают в воздух и в подходящих условиях температуры и влажности развиваются в мицелий. Словом, почва представляет собой очень мощный и насыщенный коллектор грибов.
Тяжи мицелия на поверхности почвы
Известно, что древесные остатки, изделия из различных материалов, погруженные в почву целиком или частично, постепенно разрушаются. При извлечении их из почвы можно обнаружить грибные налеты или колонии, иногда довольно разнообразные. Подземные части растений тоже часто становятся объектами нападения грибов. Все это говорит о том, что источник этой заразы — почвенные грибы. Не будет ошибкой сказать, что плесневение пищевых продуктов, разрушения различных материалов на поверхности земли тоже вызываются почвенными грибами, споры которых попадают в воздух и в подходящих условиях температуры и влажности развиваются в мицелий. Словом, почва представляет собой очень мощный и насыщенный коллектор грибов.
 Тяжи грибницы отходят от основания ножки шляпочного гриба
Число грибных зачатков, например, в 1 г средиеподзолистой почвы смешанного леса может доходить до 600 тыс., а общая длина гиф мицелия в таком же количестве почвы под различными насаждениями часто измеряется сотнями метров. Особенно насыщены мицелием верхние горизонты почвы, богатые Органическими веществами и лучше аэрируемые. В дерново-подзолистой почве на глубине 4-5 см иногда содержится на 1 га от 50 до 320 кг биомассы грибов! Даже в очень засушливых и, казалось бы, малопригодных для жизни местах, например в песках пустынь, можно обнаружить грибы. В подобных местообитаниях они часто поселяются в глубоких горизонтах, иногда около корней высших растений, так называемой ризосфере, или в подземных норах животных.
Тяжи грибницы отходят от основания ножки шляпочного гриба
Число грибных зачатков, например, в 1 г средиеподзолистой почвы смешанного леса может доходить до 600 тыс., а общая длина гиф мицелия в таком же количестве почвы под различными насаждениями часто измеряется сотнями метров. Особенно насыщены мицелием верхние горизонты почвы, богатые Органическими веществами и лучше аэрируемые. В дерново-подзолистой почве на глубине 4-5 см иногда содержится на 1 га от 50 до 320 кг биомассы грибов! Даже в очень засушливых и, казалось бы, малопригодных для жизни местах, например в песках пустынь, можно обнаружить грибы. В подобных местообитаниях они часто поселяются в глубоких горизонтах, иногда около корней высших растений, так называемой ризосфере, или в подземных норах животных.
Поверхность питательной среды с колониями микроскопических грибов из подстилки ельника (1, 2) и почвы (3, 4)
В понятие почвенные грибы включают представителей самых различных систематических групп, практически представителей всех известных классов грибов. Общим для них является место обитания. Однако в то время как одни из них проводят в почве всю жизнь, другие связаны с ней лишь в определенной части жизненного цикла. В соответствии с этим все грибы (включая макро- и микроформы) можно распределить в следующем порядке:
1. Грибы, находящиеся в почве или на растительных остатках в ней только в виде спор или покоящихся состояний (далее указаны в скобках). Большей частью это паразитические грибы из класса хитридиевых, например возбудитель рака картофе ля — один из видов рода синхитриум (цисты), из класса оомицетов — некоторые представители порядка пероноспоровых, или ложномучнеросных (ооспоры, геммы), из класса сумчатых — представители настоящих мучнеросных (клейстотеции), из класса базидиальных — виды головневых и ржавчинных грибов (головневые споры, телейтоспоры).
2. Грибы, паразитизм которых не является обязательным. К ним относятся многие факультативные паразиты подземных и надземных частей растений, например из класса оомицетов — питиум, вызывающий загнивание корневой шейки проростков многих растений, в том числе сеянцев древесных пород; виды рода афаномицес, вызывающие подобные же заболевания; из сумчатых грибов — некоторые паразиты на корнях различных культурных растений, например табака, льна и др.; из базидиальных — гипохнус соляни, поражающий картофель; из класса дейтеромицетов — некоторые представители рода фузариум и др. Все они могут очень долго жить и размножаться в почве.
3. Чисто сапротрофные формы, потребляющие для питания органические и минеральные составные части почвы. К их числу принадлежат виды пенициллов, аспергиллов, ряд мукоровых грибов, триходерма и др., т. е. огромное большинство почвенных грибов.
Почвенные грибы микологи изучают почти столетие, и все же еще многое в распространении и свойствах этих грибов не до конца выяснено. Однако некоторые закономерности свидетельствуют о широкой представленности их в почвах разных типов и громадном значении прежде всего в круговороте веществ и энергии в природе.
Установлено, что в большинстве типов почв, особенно средней полосы, максимальное скопление грибов характерно для верхних горизонтов (глубина 5-10 см от поверхности). Это так называемые гумусированные горизонты, где имеется больше органических веществ, необходимых для жизни грибов, лучшие условия влажности и аэрации. В специальных опытах было показано, что грибы, обитавшие в верхних горизонтах почвы, нуждались в большем притоке кислорода, чем те, которые встречались на больших глубинах. В кислых почвах, в частности в лесных, где меньше выражена конкуренция грибов с другими обитателями почвы — бактериями и актиномицетами, предпочитающими нейтральные почвы, грибов больше, хотя они и способны развиваться в широких пределах колебаний кислотности.
Вода — необходимое условие для нормальной жизнедеятельности грибов. Многие элементы питания становятся доступными только благодаря наличию воды. Действие некоторых веществ (токсинов и антибиотиков), выделяемых грибами в процессе их жизни, оказывается возможным тоже только при наличии водной среды. Вместе с тем доказано, что грибы могут довольствоваться очень малым количеством воды в почве, и в этом отношении они значительно более стойки к засушливым условиям, чем другие микроорганизмы. Поэтому вполне жизнедеятельные грибы, как уже упоминалось, могут быть обнаружены в почвах пустынь, в том числе в Сахаре. Особенно устойчивы к недостатку влаги некоторые виды аспергиллов, пенициллов, а также кладоспориума, альтернарий и др.
Один из важных факторов, влияющих на распространение почвенных грибов, — солнечная радиация. Особое значение она имеет для грибов, живущих в высокогорьях и пустынях. В таких местах грибы чаще всего имеют темную окраску мицелия и спор. Окраска обусловлена наличием особых пигментов меланинов, которые защищают, экранируют содержимое клетки от возможных повреждений при повышенной радиации. В горах Памира на высоте 5000 м над ур. м. в почвах содержатся только темноокрашенные грибы. Чаще других там встречаются виды родов кладоспориум и стемфилиум, много темноцветных грибов из родов стемфилиум, альтернария, акротециум, курвулярия и других обнаружено также в пустынных почвах Тянь-Шаня, Туркмении.
При сравнении комплексов грибов почв умеренных и южных широт становится очевидным преобладание темноцветных форм в почвах южных областей. Однако процент встречаемости таких грибов снова несколько повышается в тундровых и подзолистых почвах Крайнего Севера по сравнению с почвами средней полосы. Это тоже связано с повышенной радиацией в этих широтах. Интересно, что грибы здесь представлены главным образом видом рода ауреобазидиум.
В лесных почвах подзолистой зоны темноцветные грибы встречаются чаще всего в подстилке, куда они попадают уже вместе с опадом после того, как разовьются предварительно на поверхности листьев.
Опыты по облучению культур разных видов темноокрашенных грибов подтвердили их устойчивость к ультрафиолетовым и другим лучам по сравнению с беспигментными или слабоокрашенными формами. Очевидно именно поэтому такие грибы, попадая из почвы в наземные условия и занесенные воздушными течениями на большие высоты, например в стратосферу, лучше, чем другие грибы, сохраняют жизнеспособность.
Температура — тоже один из важнейших факторов распространения почвенных грибов. Для большинства из них оптимальна температура 24-28°С. Однако есть среди почвенных грибов и такие, которые предпочитают более высокие или более низкие температуры. Для первых оптимальна температура
но они могут развиваться даже при 50°С и выше, например некоторые виды аспергиллов, мукоров, гумикола, термомицес и др. Такие грибы называются термофилами. Высокие температурные требования, во-первых, обусловливают большее их распространение в хорошо прогреваемых почвах, а во-вторых, развитие их в таких местообитаниях, как навоз, компосты, в запасах грубых кормов, зерна и в других подобных, куда они попадают из почвы. В этих субстратах часто наблюдается процесс самосогревания, при котором температура сильно повышается.
Поскольку грибы реагируют на изменения влажности и температуры, не удивительно, что в течение года их количество, а отчасти и состав изменяются по сезонам года.
Поверхность питательной среды с колониями микроскопических грибов из подстилки ельника (1, 2) и почвы (3, 4)
В понятие почвенные грибы включают представителей самых различных систематических групп, практически представителей всех известных классов грибов. Общим для них является место обитания. Однако в то время как одни из них проводят в почве всю жизнь, другие связаны с ней лишь в определенной части жизненного цикла. В соответствии с этим все грибы (включая макро- и микроформы) можно распределить в следующем порядке:
1. Грибы, находящиеся в почве или на растительных остатках в ней только в виде спор или покоящихся состояний (далее указаны в скобках). Большей частью это паразитические грибы из класса хитридиевых, например возбудитель рака картофе ля — один из видов рода синхитриум (цисты), из класса оомицетов — некоторые представители порядка пероноспоровых, или ложномучнеросных (ооспоры, геммы), из класса сумчатых — представители настоящих мучнеросных (клейстотеции), из класса базидиальных — виды головневых и ржавчинных грибов (головневые споры, телейтоспоры).
2. Грибы, паразитизм которых не является обязательным. К ним относятся многие факультативные паразиты подземных и надземных частей растений, например из класса оомицетов — питиум, вызывающий загнивание корневой шейки проростков многих растений, в том числе сеянцев древесных пород; виды рода афаномицес, вызывающие подобные же заболевания; из сумчатых грибов — некоторые паразиты на корнях различных культурных растений, например табака, льна и др.; из базидиальных — гипохнус соляни, поражающий картофель; из класса дейтеромицетов — некоторые представители рода фузариум и др. Все они могут очень долго жить и размножаться в почве.
3. Чисто сапротрофные формы, потребляющие для питания органические и минеральные составные части почвы. К их числу принадлежат виды пенициллов, аспергиллов, ряд мукоровых грибов, триходерма и др., т. е. огромное большинство почвенных грибов.
Почвенные грибы микологи изучают почти столетие, и все же еще многое в распространении и свойствах этих грибов не до конца выяснено. Однако некоторые закономерности свидетельствуют о широкой представленности их в почвах разных типов и громадном значении прежде всего в круговороте веществ и энергии в природе.
Установлено, что в большинстве типов почв, особенно средней полосы, максимальное скопление грибов характерно для верхних горизонтов (глубина 5-10 см от поверхности). Это так называемые гумусированные горизонты, где имеется больше органических веществ, необходимых для жизни грибов, лучшие условия влажности и аэрации. В специальных опытах было показано, что грибы, обитавшие в верхних горизонтах почвы, нуждались в большем притоке кислорода, чем те, которые встречались на больших глубинах. В кислых почвах, в частности в лесных, где меньше выражена конкуренция грибов с другими обитателями почвы — бактериями и актиномицетами, предпочитающими нейтральные почвы, грибов больше, хотя они и способны развиваться в широких пределах колебаний кислотности.
Вода — необходимое условие для нормальной жизнедеятельности грибов. Многие элементы питания становятся доступными только благодаря наличию воды. Действие некоторых веществ (токсинов и антибиотиков), выделяемых грибами в процессе их жизни, оказывается возможным тоже только при наличии водной среды. Вместе с тем доказано, что грибы могут довольствоваться очень малым количеством воды в почве, и в этом отношении они значительно более стойки к засушливым условиям, чем другие микроорганизмы. Поэтому вполне жизнедеятельные грибы, как уже упоминалось, могут быть обнаружены в почвах пустынь, в том числе в Сахаре. Особенно устойчивы к недостатку влаги некоторые виды аспергиллов, пенициллов, а также кладоспориума, альтернарий и др.
Один из важных факторов, влияющих на распространение почвенных грибов, — солнечная радиация. Особое значение она имеет для грибов, живущих в высокогорьях и пустынях. В таких местах грибы чаще всего имеют темную окраску мицелия и спор. Окраска обусловлена наличием особых пигментов меланинов, которые защищают, экранируют содержимое клетки от возможных повреждений при повышенной радиации. В горах Памира на высоте 5000 м над ур. м. в почвах содержатся только темноокрашенные грибы. Чаще других там встречаются виды родов кладоспориум и стемфилиум, много темноцветных грибов из родов стемфилиум, альтернария, акротециум, курвулярия и других обнаружено также в пустынных почвах Тянь-Шаня, Туркмении.
При сравнении комплексов грибов почв умеренных и южных широт становится очевидным преобладание темноцветных форм в почвах южных областей. Однако процент встречаемости таких грибов снова несколько повышается в тундровых и подзолистых почвах Крайнего Севера по сравнению с почвами средней полосы. Это тоже связано с повышенной радиацией в этих широтах. Интересно, что грибы здесь представлены главным образом видом рода ауреобазидиум.
В лесных почвах подзолистой зоны темноцветные грибы встречаются чаще всего в подстилке, куда они попадают уже вместе с опадом после того, как разовьются предварительно на поверхности листьев.
Опыты по облучению культур разных видов темноокрашенных грибов подтвердили их устойчивость к ультрафиолетовым и другим лучам по сравнению с беспигментными или слабоокрашенными формами. Очевидно именно поэтому такие грибы, попадая из почвы в наземные условия и занесенные воздушными течениями на большие высоты, например в стратосферу, лучше, чем другие грибы, сохраняют жизнеспособность.
Температура — тоже один из важнейших факторов распространения почвенных грибов. Для большинства из них оптимальна температура 24-28°С. Однако есть среди почвенных грибов и такие, которые предпочитают более высокие или более низкие температуры. Для первых оптимальна температура
но они могут развиваться даже при 50°С и выше, например некоторые виды аспергиллов, мукоров, гумикола, термомицес и др. Такие грибы называются термофилами. Высокие температурные требования, во-первых, обусловливают большее их распространение в хорошо прогреваемых почвах, а во-вторых, развитие их в таких местообитаниях, как навоз, компосты, в запасах грубых кормов, зерна и в других подобных, куда они попадают из почвы. В этих субстратах часто наблюдается процесс самосогревания, при котором температура сильно повышается.
Поскольку грибы реагируют на изменения влажности и температуры, не удивительно, что в течение года их количество, а отчасти и состав изменяются по сезонам года.
 Верхушка конидиеносцев пеницилла (1) и аспергилла (2); микросъемка с разным увеличением
Установлено, что пенициллы преобладают в почвах северных широт, а аспергиллов гораздо больше в почвах южных областей и они почти не встречаются в почвах тундры, где ограничивающим фактором для развития грибов является прежде всего температура. Эта закономерность распространения грибов проявляется не только в широтном, но и в высотном направлениях, т. е. чем выше местность над уровнем моря, тем меньше будет в почве аспергиллов и больше пенициллов.
При сравнении особенностей роста изолятов грибов одного и того же вида, но из разных местообитаний, обнаруживается, что те из них, которые были выделены из южных почв, характеризуются более высокими темпами развития при более высоких температурах, а при низких температурах не растут вообще в то время как для изолятов из тундр, например, оптимальны более низкие температуры. В этом проявляется приспособление разных экологических форм одного и того же вида к условиям обитания.
Говоря о распространении почвенных микроскопических грибов, нельзя, однако, обойти вниманием случаи, когда они развиваются в почве, но в своеобразных, специфических местообитаниях, где условия окружающей среды не оказывают на них губительного воздействия. Например, в гнездах термитов в засушливых районах Туркмении обнаружено 28 видов грибов дейтеромицетов, главным образом аспергиллов и пенициллов, и 3 вида дрожжей. Колебания температуры и влажности в термитниках менее резки, чем на поверхности и в окружающей почве, так как термитник имеет ячеистое строение, пронизан многочисленными ходами, соединяющими разные камеры и ведущими в глубь почвы на несколько метров, до уровня грунтовых вод. В термитнике есть царская камера, где живут царь и царица термитов, жилые и кормовые камеры, камеры с экскрементами и камеры-могильники, куда термиты помещают трупы погибших сородичей и других насекомых. В камерах могильниках и камерах с экскрементами термитов грибов бывает особенно много. Там они находят для себя наиболее благоприятные условия: имеется пища в виде растительных остатков, создается определенная нужная влажность субстрата за счет испарения воды самими термитами и впитыванием ее экскрементами и стенками камер. Глубже 30 см температура в термитнике в самое жаркое время не превышает 30-32°С.
Нечто подобное наблюдается в норах грызунов, например в норе большой песчанки в Урало-Эмбинском междуречье, которая является основным носителем чумы. В норах этой песчанки живут насекомые-кровососы — переносчики заболевания. При изучении грибов и бактерий этих нор с целью обнаружения видов микроорганизмов, которые можно использовать для биологической борьбы с насекомыми — возможными переносчиками, было обнаружено 44 вида почвенных грибов, причем они были найдены на всем протяжении норных ходов и камер до глубины более 1 м. Условия температуры и влажности здесь были вполне подходящими для жизни этих грибов.
Верхушка конидиеносцев пеницилла (1) и аспергилла (2); микросъемка с разным увеличением
Установлено, что пенициллы преобладают в почвах северных широт, а аспергиллов гораздо больше в почвах южных областей и они почти не встречаются в почвах тундры, где ограничивающим фактором для развития грибов является прежде всего температура. Эта закономерность распространения грибов проявляется не только в широтном, но и в высотном направлениях, т. е. чем выше местность над уровнем моря, тем меньше будет в почве аспергиллов и больше пенициллов.
При сравнении особенностей роста изолятов грибов одного и того же вида, но из разных местообитаний, обнаруживается, что те из них, которые были выделены из южных почв, характеризуются более высокими темпами развития при более высоких температурах, а при низких температурах не растут вообще в то время как для изолятов из тундр, например, оптимальны более низкие температуры. В этом проявляется приспособление разных экологических форм одного и того же вида к условиям обитания.
Говоря о распространении почвенных микроскопических грибов, нельзя, однако, обойти вниманием случаи, когда они развиваются в почве, но в своеобразных, специфических местообитаниях, где условия окружающей среды не оказывают на них губительного воздействия. Например, в гнездах термитов в засушливых районах Туркмении обнаружено 28 видов грибов дейтеромицетов, главным образом аспергиллов и пенициллов, и 3 вида дрожжей. Колебания температуры и влажности в термитниках менее резки, чем на поверхности и в окружающей почве, так как термитник имеет ячеистое строение, пронизан многочисленными ходами, соединяющими разные камеры и ведущими в глубь почвы на несколько метров, до уровня грунтовых вод. В термитнике есть царская камера, где живут царь и царица термитов, жилые и кормовые камеры, камеры с экскрементами и камеры-могильники, куда термиты помещают трупы погибших сородичей и других насекомых. В камерах могильниках и камерах с экскрементами термитов грибов бывает особенно много. Там они находят для себя наиболее благоприятные условия: имеется пища в виде растительных остатков, создается определенная нужная влажность субстрата за счет испарения воды самими термитами и впитыванием ее экскрементами и стенками камер. Глубже 30 см температура в термитнике в самое жаркое время не превышает 30-32°С.
Нечто подобное наблюдается в норах грызунов, например в норе большой песчанки в Урало-Эмбинском междуречье, которая является основным носителем чумы. В норах этой песчанки живут насекомые-кровососы — переносчики заболевания. При изучении грибов и бактерий этих нор с целью обнаружения видов микроорганизмов, которые можно использовать для биологической борьбы с насекомыми — возможными переносчиками, было обнаружено 44 вида почвенных грибов, причем они были найдены на всем протяжении норных ходов и камер до глубины более 1 м. Условия температуры и влажности здесь были вполне подходящими для жизни этих грибов.
Грибы и процесс почвообразования
Почвенные грибы так же, как высшие растения и животные, населяющие почву, принимают активное участие в почвообразовательных процессах, сущность которых заключается в разрушении и создании органического вещества. В этом и состоит основная роль грибов в почве. Уже отмечалось, что грибы, в том числе и почвенные, являются гетеротрофными организмами, т. е. нуждаются в готовых органических веществах. Они находят их в природе в виде органических остатков или в виде других живых организмов, т. е. существуют или как сапротрофы, или как паразиты растений, животных, других грибов. Иногда невозможно провести резкую грань между этими типами существования, так как они бывают связаны переходами. Большинство почвенных грибов-сапротрофов отличается широкой амплитудой приспособления к источникам пищи, поэтому один и тот же вид гриба может иногда поселяться на органических остатках различного происхождения. В то же время на одном и том же субстрате, содержащем органические вещества, могут одновременно развиваться различные виды грибов, и тогда между ними иногда складываются очень сложные взаимоотношения взаимопомощи или конкуренции. Чаще бывает так, что процесс разложения органического вещества осуществляется целым комплексом грибов, не говоря уже о других организмах, принимающих участие в этом процессе. Имеются среди почвенных грибов и узкие "специалисты",приспособившиеся к каким-то своеобразным субстратам, где у них нет конкурентов. В природе ежегодно происходит отмирание различных растений и их частей. Основными разрушителями растительных остатков являются грибы. Это обусловлено в первую очередь кислой реакцией растительных субстратов, которая благоприятствует росту и развитию грибов, и наличием у грибов соответствующих ферментов. Если бы в природе не существовало грибов, вся поверхность Земли вскоре оказалась бы покрытой остатками растений. В составе растительных остатков по массе преобладают материалы клеточной стенки растений, т. е. клетчатка, или целлюлоза, гемицеллюлозы и лигнин — сложные соединения, в состав которых входит углерод. Следовательно, грибам принадлежит очень существенная роль в круговороте углерода. Весь процесс разрушения остатков корневых систем растений или их частей происходит непосредственно в почве. Однако в лесу он идет иначе, чем на лугу или в поле, и осуществляется иными грибами. Причина этого заключается в том, что для каждого из перечисленных местообитаний характерны свои комплексы грибов, определяемые различиями физико-химических свойств почвы, влажности, температуры и т. д. Бывает так, что иногда процессу разрушения подвергается живой корень, если на него нападает почвенный гриб-паразит. Осенний опенок, например, является опасным паразитом древесных пород, особенно осины, березы и других деревьев. Он образует хорошо выраженные тяжи из гиф мицелия, протягивает их вдоль корня, и как только такой тяж наткнется на поврежденный участок корня (повреждения часто вызываются животными или насекомыми), гифы тяжа в этом месте тотчас же внедряются в корень, распространяются в нем, а тяж тянется дальше, вновь находит слабое место, и опять гифы входят внутрь корня. Наконец сопротивление дерева ослабляется под действием гиф, и гриб быстро распространяется уже не только в корне, но и в стволовой части, вызывая периферическую белую гниль, которая обнаруживается в стволе иногда на высоте до 3 м, а иногда и выше. Молодые деревья погибают очень быстро после внедрения паразита, а более взрослые могут болеть в течение нескольких лет. Листья их преждевременно желтеют и опадают, а осенью (с конца августа и иногда до заморозков) в основании стволов могут уже появляться плодовые тела опенка. Дерево усыхает, гибнет, ломается от ветра, а на оставшихся частях стволов и пнях развиваются группы плодовых тел гриба. Корни других деревьев могут быстро заразиться грибницей при контакте с корнями уже зараженных. Тяжи, или ризоморфы, опенка могут переходить и на здоровые корни через почву или растительные остатки. Молодая елочка, погибшая от поражения опенком осенним
Не менее опасный паразит корней деревьев — корневая губка, которая попадает в корни тоже в виде мицелия из почвы; иногда ею заражаются свежесрубленные пни при попадании на них спор этого гриба. Споры прорастают затем в мицелий, внедряющийся в пень, а оттуда он проникает в почву и заражает другие деревья. Для борьбы с этим паразитом наряду с корчеванием зараженных пней был предложен метод биологической борьбы — нанесение на поверхность свежесрубленного пня споровой суспензии какого-либо хорошо и быстро растущего сапротрофного гриба, который распространяется на пне и в его толще, т. е. быстро захватывает субстрат и, таким образом, предотвращает возможность заражения пня корневой губкой.
Нечто подобное происходит в том случае, когда корневая система дерева поражается сначала не такими сильными паразитами, как корневая губка или опенок, а более слабыми, например видами рода фузариум. Обычно вслед за ними в отмирающий корень внедряются грибы-сапротрофы (аспергиллы, пенициллы и др.), быстро растущие и образующие много спор, что позволяет им активно захватывать субстрат. Они усваивают легкодоступные вещества клеток растений, главным образом сахара. Затем другие грибы (ризопус, триходерма) используют более труднодоступные гемицеллюлозы и крахмал. Паразит, не выдерживая конкуренции с этими грибами, уступает им поле боя. В процессе разрушения указанные грибы образуют органические кислоты (лимонную, яблочную и др.), что создает благоприятные условия для развития грибов следующей стадии. Процесс разрушения завершают грибы, воздействующие на еще более прочные материалы клеточной стенки — целлюлозу, или клетчатку, и лигнин. Целлюлозу разрушают виды рода хетомиум из сумчатых грибов, виды родов триходерма, стахиботрис, дикоккум и др. из дейтеромицетов и многие базидиальные грибы.
Лигнин, составляющий от 18 до 30% одревесневших тканей растений, наиболее устойчивый компонент растительных остатков, разрушается главным образом базидиальными грибами, живущими в подстилке, — говорушками, коллибиями, негниючниками, миценами и др. Многие из них разрушают одновременно и целлюлозу и лигнин. Исследованиями установлено, что в процессе разложения растительных остатков (комплексном процессе разрушения лигнина) в различных типах леса участвуют и некоторые дейтеромицеты — фузариум, триходерма, стемфилиум, альтернария.
Существенным компонентом растительных тканей является пектин, который пропитывает и склеивает оболочки клеток стеблей, плодов, корней, семян многих растений. Ферменты, разлагающие пектин, встречаются у различных видов бактерий и у грибов, в том числе почвенных мукоровых, дейтеромицетов (аспергиллов, пенициллов, вертициллов, фузариумов, ботритис, склеротиний и др.). Известная на Руси с давних времен так называемая росяная мочка льна и конопли основана как раз на том, что при расстилании растений на лугах во влажную погоду, при обильной росе, на них происходит массовое развитие микроскопических грибов, в том числе почвенного мукорового гриба — мукора зимнего, ферменты которого, растворяя пектин, разъединяют волокна растений. Пектолитический фермент одного из почвенных грибов рода пеницилл используется, в частности, для осветления фруктовых соков.
Молодая елочка, погибшая от поражения опенком осенним
Не менее опасный паразит корней деревьев — корневая губка, которая попадает в корни тоже в виде мицелия из почвы; иногда ею заражаются свежесрубленные пни при попадании на них спор этого гриба. Споры прорастают затем в мицелий, внедряющийся в пень, а оттуда он проникает в почву и заражает другие деревья. Для борьбы с этим паразитом наряду с корчеванием зараженных пней был предложен метод биологической борьбы — нанесение на поверхность свежесрубленного пня споровой суспензии какого-либо хорошо и быстро растущего сапротрофного гриба, который распространяется на пне и в его толще, т. е. быстро захватывает субстрат и, таким образом, предотвращает возможность заражения пня корневой губкой.
Нечто подобное происходит в том случае, когда корневая система дерева поражается сначала не такими сильными паразитами, как корневая губка или опенок, а более слабыми, например видами рода фузариум. Обычно вслед за ними в отмирающий корень внедряются грибы-сапротрофы (аспергиллы, пенициллы и др.), быстро растущие и образующие много спор, что позволяет им активно захватывать субстрат. Они усваивают легкодоступные вещества клеток растений, главным образом сахара. Затем другие грибы (ризопус, триходерма) используют более труднодоступные гемицеллюлозы и крахмал. Паразит, не выдерживая конкуренции с этими грибами, уступает им поле боя. В процессе разрушения указанные грибы образуют органические кислоты (лимонную, яблочную и др.), что создает благоприятные условия для развития грибов следующей стадии. Процесс разрушения завершают грибы, воздействующие на еще более прочные материалы клеточной стенки — целлюлозу, или клетчатку, и лигнин. Целлюлозу разрушают виды рода хетомиум из сумчатых грибов, виды родов триходерма, стахиботрис, дикоккум и др. из дейтеромицетов и многие базидиальные грибы.
Лигнин, составляющий от 18 до 30% одревесневших тканей растений, наиболее устойчивый компонент растительных остатков, разрушается главным образом базидиальными грибами, живущими в подстилке, — говорушками, коллибиями, негниючниками, миценами и др. Многие из них разрушают одновременно и целлюлозу и лигнин. Исследованиями установлено, что в процессе разложения растительных остатков (комплексном процессе разрушения лигнина) в различных типах леса участвуют и некоторые дейтеромицеты — фузариум, триходерма, стемфилиум, альтернария.
Существенным компонентом растительных тканей является пектин, который пропитывает и склеивает оболочки клеток стеблей, плодов, корней, семян многих растений. Ферменты, разлагающие пектин, встречаются у различных видов бактерий и у грибов, в том числе почвенных мукоровых, дейтеромицетов (аспергиллов, пенициллов, вертициллов, фузариумов, ботритис, склеротиний и др.). Известная на Руси с давних времен так называемая росяная мочка льна и конопли основана как раз на том, что при расстилании растений на лугах во влажную погоду, при обильной росе, на них происходит массовое развитие микроскопических грибов, в том числе почвенного мукорового гриба — мукора зимнего, ферменты которого, растворяя пектин, разъединяют волокна растений. Пектолитический фермент одного из почвенных грибов рода пеницилл используется, в частности, для осветления фруктовых соков.
 Мицены — разрушители лигнина и целлюлозы растительных тканей
Растительные остатки в лесу накапливаются в виде подстилки, биомасса которой в хвойном лесу, например, составляет иногда 300 ц/га, а в широколиственном примерно 150 ц/га. В подстилке лиственного леса различают слои: верхний, состоящий из опада, только слегка тронутого разложением; средний, в котором растительные остатки полуразложились; нижний, сильно разложившийся слой, в котором, помимо органического вещества, можно обнаружить и примесь минеральных частиц. В верхнем слое подстилки присутствует ряд грибов — слабых паразитов, которые попадают сюда вместе с листьями, поселившись на них тогда, когда они были живыми или по крайней мере находились на ветвях дерева. Эти грибы представлены видами родов микосферелла, кладоспориум, альтернария, ауреобазидиум, фома и др. В среднем, наиболее биогенном слое их сменяют другие грибы — подстилочные сапротрофы из базидиальных грибов и почвенные мукоровые грибы (из родов мортиерелла, тиегемелла), сумчатые (виды хетомиум) и дейтеромицеты (главным образом пенициллы). И, наконец, в нижнем слое помимо видов, характерных для предыдущего слоя, присутствует уже свой набор видов (аспергиллы, виды хризоспориум и др.), завершающих процесс разложения. Мы только для примера назвали некоторые виды грибов — участников этих процессов, так как даже в различных типах леса (не говоря уже о специфике процесса разложения растительных остатков в поле и степи) на разных этапах разложения образуются разные комплексы грибов.
Мицены — разрушители лигнина и целлюлозы растительных тканей
Растительные остатки в лесу накапливаются в виде подстилки, биомасса которой в хвойном лесу, например, составляет иногда 300 ц/га, а в широколиственном примерно 150 ц/га. В подстилке лиственного леса различают слои: верхний, состоящий из опада, только слегка тронутого разложением; средний, в котором растительные остатки полуразложились; нижний, сильно разложившийся слой, в котором, помимо органического вещества, можно обнаружить и примесь минеральных частиц. В верхнем слое подстилки присутствует ряд грибов — слабых паразитов, которые попадают сюда вместе с листьями, поселившись на них тогда, когда они были живыми или по крайней мере находились на ветвях дерева. Эти грибы представлены видами родов микосферелла, кладоспориум, альтернария, ауреобазидиум, фома и др. В среднем, наиболее биогенном слое их сменяют другие грибы — подстилочные сапротрофы из базидиальных грибов и почвенные мукоровые грибы (из родов мортиерелла, тиегемелла), сумчатые (виды хетомиум) и дейтеромицеты (главным образом пенициллы). И, наконец, в нижнем слое помимо видов, характерных для предыдущего слоя, присутствует уже свой набор видов (аспергиллы, виды хризоспориум и др.), завершающих процесс разложения. Мы только для примера назвали некоторые виды грибов — участников этих процессов, так как даже в различных типах леса (не говоря уже о специфике процесса разложения растительных остатков в поле и степи) на разных этапах разложения образуются разные комплексы грибов.
 Рост характерного для почв хвойного леса гриба мортиерелла: а — без проростков ели (мицельный рост); б — с проростками ели (колоннии больше и спороносят)
Процессы разложения в подстилке и почве очень сложны, идут в несколько этапов и осуществляются на этих этапах разными видами грибов, т. е. происходит, как говорят, сукцессия видов грибов, набор которых определяется всей экологической обстановкой, начиная с характера субстрата и кончая типом почвы, физико-химическими условиями и т. п. В частности, на основании приведенных выше цифр, характеризующих мощность подстилки хвойного и широколиственного леса, уже можно сделать вывод о том, что в хвойном лесу процесс разложения идет значительно медленнее, что связано с характером опада. Процесс разложения подстилки в значительной степени зависит также от влажности — необходимого условия развития грибов.
Процессы разложения так называемой деловой древесины (шпалы, крепежный лес в шахтах и т. п.) тоже часто происходят в почве. Основные разрушители ее — базидиальные грибы, но, как выяснилось работами последних лет, и здесь немаловажную роль выполняют микроскопические почвенные грибы. Дело в том, что такая древесина в целях защиты от грибов-древоразрушителей обычно пропитывается специальными антисептиками, а микроскопические почвенные грибы, поселяясь на ней, разрушают эти . антисептики, после чего открывается доступ в нее основным древоразрушителям.
Интересны связи и взаимоотношения между компонентами в сукцессиях грибов. Уже отмечалось, что быстрорастущие и появляющиеся на первых этапах разложения древесных материалов грибы образуют органические кислоты, чем создают более благоприятные условия для развития грибов последующих стадий разложения.
Некоторые виды микроскопических грибов могут использовать для своей жизнедеятельности вещества, образующиеся после отмирания мицелия грибов предшествующей стадии, в частности разрушать вещества клеточных стенок грибов. Это виды родов мукор, мортиерелла, аспергиллы и др.
Определенные взаимоотношения складываются между грибами и почвенными бактериями. Известно, что базидиальные грибы — подстилочные сапротрофы благоприятствуют развитию аммонифицирующих бактерий, что же касается микроскопических почвенных грибов, то они проявляют антагонизм к целлюлозоразру-шающим бактериям, являющимся их конкурентами в этом процессе. На почве конкуренции между организмами у грибов выработались в процессе эволюции такие средства подавления своих противников, как антибиотики. Вместе с тем специально проведенные опыты показали, что микроскопические почвенные грибы обычно не угнетают развитие грибов — подстилочных сапротрофов.
Процессы разложения органического вещества происходят не только в почве или на ее поверхности, но и в наземных условиях и примерно по такой же, как и описанная выше, схеме.
Почвенные микроскопические грибы принимают участие в круговороте не только углерода, но и азота. Остатки растений и животных, содержащие азот, попадают в почву, где разрушаются бактериями, актиномицетами и грибами. Например, в черноземах из 10 т соединений азота, приходящихся на 1 га, 90% азота находится в форме органических соединений- белков, мочевины мочевой кислоты и др. Особенно активные участники превращений этих соединений — мукоровые грибы, виды аспергиллов, триходермы и др. Почти все они способны также усваивать азот аммонийных соединений, но далеко не все — нитратный азот. Это соединение очень хорошо усваивается почвенным грибом аспергиллом черным.
Известно, что при недостатке в почве безазотистого органического питания (углеводов) в ней накапливается значительное количество аммиака, образующегося в результате деятельности мукоровых грибов при разложении аммонийных соединений азота. Если в почве углеводов много, мукоровые грибы могут энергично усваивать растворимые минеральные соединения азота (нитраты, те же аммонийные соединения) и переводить их в белки своего тела. Благодаря этому уменьшается вымывание азотистых веществ из почвы, так как они закрепляются в мицелии грибов.
В почву попадают и такие специфические вещества, как перья птиц, копыта и рога животных, остатки их волосяного покрова, хитиновые оболочки насекомых и других животных. На них развиваются специфические комплексы грибов, в конечном счете приводящие их к полной деградации. Птичьи перья, рога, копыта, волосы состоят из кератина, который под воздействием грибов размягчается и растворяется. Соответствующие грибы можно "выманить" из почвы, если на ней поместить отмытые и обезжиренные волосы, а потом уже можно выделить эти грибы на питательной среде с целью их изучения. При просмотре таких волос под микроскопом при сильном увеличении в них можно видеть гифы грибов. Из грибов, разлагающих кератин, можно назвать онигену лошадиную, развивающуюся на копытах и рогах, онигену воронью — на перьях и волосах, а также типичного почвенного разрушителя кератина — кератиномицеса айеллои. Чаще всего такие грибы встречаются в почвах богатых органическими веществами — в местах выпаса скота, садах.
Не менее прочное, чем кератин, и трудноразлагаемое вещество — хитин. Он содержится в покровных тканях насекомых и многих других обитателей почвы, в клеточных стенках мицелия грибов. Основные разрушители хитина в почве — актиномицеты или, как их раньше называли, лучистые грибки (теперь их относят к бактериям). Некоторые микроскопические почвенные грибы тоже обладают этой способностью, и их можно также выделять, пользуясь методом приманок. Относятся эти грибы к видам родов мукор, мортиерелла, аспергилл, хетомиум, тиелавиопсис и др. Особенно активная роль в разрушении хитина приписывается грибу аспергиллу дымчатому.
Есть гриб, который приурочен к почвам, пропитанным нефтью, и часто развивается на керосине, креозоте, дизельных топливах, различных смазках. Это кладоспориум смолистый, или керосиновый гриб.
Рост характерного для почв хвойного леса гриба мортиерелла: а — без проростков ели (мицельный рост); б — с проростками ели (колоннии больше и спороносят)
Процессы разложения в подстилке и почве очень сложны, идут в несколько этапов и осуществляются на этих этапах разными видами грибов, т. е. происходит, как говорят, сукцессия видов грибов, набор которых определяется всей экологической обстановкой, начиная с характера субстрата и кончая типом почвы, физико-химическими условиями и т. п. В частности, на основании приведенных выше цифр, характеризующих мощность подстилки хвойного и широколиственного леса, уже можно сделать вывод о том, что в хвойном лесу процесс разложения идет значительно медленнее, что связано с характером опада. Процесс разложения подстилки в значительной степени зависит также от влажности — необходимого условия развития грибов.
Процессы разложения так называемой деловой древесины (шпалы, крепежный лес в шахтах и т. п.) тоже часто происходят в почве. Основные разрушители ее — базидиальные грибы, но, как выяснилось работами последних лет, и здесь немаловажную роль выполняют микроскопические почвенные грибы. Дело в том, что такая древесина в целях защиты от грибов-древоразрушителей обычно пропитывается специальными антисептиками, а микроскопические почвенные грибы, поселяясь на ней, разрушают эти . антисептики, после чего открывается доступ в нее основным древоразрушителям.
Интересны связи и взаимоотношения между компонентами в сукцессиях грибов. Уже отмечалось, что быстрорастущие и появляющиеся на первых этапах разложения древесных материалов грибы образуют органические кислоты, чем создают более благоприятные условия для развития грибов последующих стадий разложения.
Некоторые виды микроскопических грибов могут использовать для своей жизнедеятельности вещества, образующиеся после отмирания мицелия грибов предшествующей стадии, в частности разрушать вещества клеточных стенок грибов. Это виды родов мукор, мортиерелла, аспергиллы и др.
Определенные взаимоотношения складываются между грибами и почвенными бактериями. Известно, что базидиальные грибы — подстилочные сапротрофы благоприятствуют развитию аммонифицирующих бактерий, что же касается микроскопических почвенных грибов, то они проявляют антагонизм к целлюлозоразру-шающим бактериям, являющимся их конкурентами в этом процессе. На почве конкуренции между организмами у грибов выработались в процессе эволюции такие средства подавления своих противников, как антибиотики. Вместе с тем специально проведенные опыты показали, что микроскопические почвенные грибы обычно не угнетают развитие грибов — подстилочных сапротрофов.
Процессы разложения органического вещества происходят не только в почве или на ее поверхности, но и в наземных условиях и примерно по такой же, как и описанная выше, схеме.
Почвенные микроскопические грибы принимают участие в круговороте не только углерода, но и азота. Остатки растений и животных, содержащие азот, попадают в почву, где разрушаются бактериями, актиномицетами и грибами. Например, в черноземах из 10 т соединений азота, приходящихся на 1 га, 90% азота находится в форме органических соединений- белков, мочевины мочевой кислоты и др. Особенно активные участники превращений этих соединений — мукоровые грибы, виды аспергиллов, триходермы и др. Почти все они способны также усваивать азот аммонийных соединений, но далеко не все — нитратный азот. Это соединение очень хорошо усваивается почвенным грибом аспергиллом черным.
Известно, что при недостатке в почве безазотистого органического питания (углеводов) в ней накапливается значительное количество аммиака, образующегося в результате деятельности мукоровых грибов при разложении аммонийных соединений азота. Если в почве углеводов много, мукоровые грибы могут энергично усваивать растворимые минеральные соединения азота (нитраты, те же аммонийные соединения) и переводить их в белки своего тела. Благодаря этому уменьшается вымывание азотистых веществ из почвы, так как они закрепляются в мицелии грибов.
В почву попадают и такие специфические вещества, как перья птиц, копыта и рога животных, остатки их волосяного покрова, хитиновые оболочки насекомых и других животных. На них развиваются специфические комплексы грибов, в конечном счете приводящие их к полной деградации. Птичьи перья, рога, копыта, волосы состоят из кератина, который под воздействием грибов размягчается и растворяется. Соответствующие грибы можно "выманить" из почвы, если на ней поместить отмытые и обезжиренные волосы, а потом уже можно выделить эти грибы на питательной среде с целью их изучения. При просмотре таких волос под микроскопом при сильном увеличении в них можно видеть гифы грибов. Из грибов, разлагающих кератин, можно назвать онигену лошадиную, развивающуюся на копытах и рогах, онигену воронью — на перьях и волосах, а также типичного почвенного разрушителя кератина — кератиномицеса айеллои. Чаще всего такие грибы встречаются в почвах богатых органическими веществами — в местах выпаса скота, садах.
Не менее прочное, чем кератин, и трудноразлагаемое вещество — хитин. Он содержится в покровных тканях насекомых и многих других обитателей почвы, в клеточных стенках мицелия грибов. Основные разрушители хитина в почве — актиномицеты или, как их раньше называли, лучистые грибки (теперь их относят к бактериям). Некоторые микроскопические почвенные грибы тоже обладают этой способностью, и их можно также выделять, пользуясь методом приманок. Относятся эти грибы к видам родов мукор, мортиерелла, аспергилл, хетомиум, тиелавиопсис и др. Особенно активная роль в разрушении хитина приписывается грибу аспергиллу дымчатому.
Есть гриб, который приурочен к почвам, пропитанным нефтью, и часто развивается на керосине, креозоте, дизельных топливах, различных смазках. Это кладоспориум смолистый, или керосиновый гриб.
 Почвенный гриб кератиномицес айеллои внутри волоса
Почвенные грибы участвуют в процессах почвообразования, не только разрушая различные вещества, попадающие в почву. Грибы способствуют и оструктуриванию почвы или, иначе говоря, образованию деятельного или активного перегноя. Особенно важна роль грибов, живущих в тяжелых глинистых и суглинистых почвах, так как оструктуривание их грибами увеличивает аэрируемость и улучшает снабжение их водой.
В конце XIX в. образование комочков почвы приписывалось исключительно деятельности дождевых червей, позже на первый план выступили физико-химические свойства почвы, т. е. образование почвенной структуры связывалось с действием растворимых солей кальция, магния, калия, обладающих осаждающей способностью, а затем снова возникли биологические теории структурообразования, в том числе было доказано участие в этом процессе грибов. Оказалось, что выделяемые почвенными грибами вещества как бы склеивают почвенные частички друг с другом. Этому же способствуют и сами нити грибницы, оплетающие и пронизывающие частички. Даже тогда, когда грибница отмирает, продукты ее разложения продолжают выполнять эту функцию.
Многие почвенные грибы являются хорошими структурообразователями, но, как показали опыты, особенно сильной агрегирующей способностью обладают некоторые мукоровые (виды родов мукор, ризопус, абсидия), сумчатые (виды рода хетомиум), некоторые дейтеромицеты (виды родов триходерма, аспергилл, фузариум). Часто внесение этих грибов в почву вместе со свободно живущей азотфиксирующей почвенной бактерией азотобактером хроококкум способствовало более хорошему росту бактерии, что также улучшало структуру почвы.
Деятельность грибов в почве не ограничивается, однако, теми процессами, о которых было сказано. Существует мнение, что образование и разрушение гумуса также связано с деятельностью почвенных грибов и в процессе их жизни и после гибели мицелия в окружающую среду обильно выделяются вещества, которые могут принимать участие в синтезе гумуса. В частности, некоторые аспергиллы и пенициллы, темноокрашенные дейтеромицеты выделяют пигменты и антибиотические вещества, способные соединяться с другими азотсодержащими продуктами разложения органических веществ, в том числе белками (аминокислотами, пептидами), продуктами деградации лигнина, и образовывать комплексы, сходные с гуминовыми кислотами, входящими в состав гумуса. Особое значение в этом процессе имеют как раз темные пигменты, присущие многим почвенным грибам, особенно дейтеромицетам. Оказалось, что эти пигменты (меланины) по ряду химических и физических свойств очень сходны с гуминовыми кислотами.
Некоторые почвенные грибы способны и разлагать гумус, использовать его в качестве единственного источника углерода и азота. Например, присутствующий в некоторых почвах пеницилл частый освобождает в ходе этого процесса азот, который может быть использован высшими растениями.
В состав гумуса входит фосфор — элемент, необходимый для нормального роста и развития высших растений. Грибы, в частности пенициллы, образующие органические кислоты, активно участвуют в превращении нерастворимого фосфора в растворимый и, следовательно, доступный высшим растениям.
Таким образом, почвенные грибы представляют собой чрезвычайно активную группу, принимающую важное участие в процессах почвообразования. Своими ферментами они содействуют разложению различных материалов, попадающих в почву, и переводят часть переработанных веществ в компоненты своего тела. Другие части или отлагаются в почве, меняя ее химический состав и свойства, или используются и перерабатываются другими организмами. Многие почвенные грибы воздействуют и на минеральную основу почвы органическими кислотами, которые образуются и накапливаются при разложении этими грибами различных составных частей растительных клеток. Особенно активно накопление этих кислот протекает в подзолистых лесных почвах, в которых грибы представлены многочисленными видами пенициллов. В результате этого отдельные зольные элементы переходят в растворенное состояние, происходит разложение минералов, образование комплексных соединений, перемещающихся в нижележащие слои почвы, — развивается процесс подзолообразования.
Нельзя не упомянуть и о роли почвенных грибов в токсикозе почв. Некоторые виды грибов выделяют в почву ядовитые вещества — токсины, и почва при этом часто становится токсичной для высших растений. Частый случай токсикоза почв — почвоутомление. Оно заключается в том, что растения на таких почвах угнетаются, снижают урожайность. Особенно часто это бывает, когда в течение многих лет на одном и том же месте возделывается какая-нибудь одна культура. Токсикоз почв отражается и на почвенных микроорганизмах, причем иногда это совпадает с угнетением развития высших растений. Как выяснилось, наибольшее количество токсичных видов среди пенициллов. Токсичны и некоторые виды родов триходерма, фузариум, альтернария, аспергиллы и др. Все они выделяют вещества, могущие подавлять прорастание семян растений.
Длительность сохранения токсинов в почве различна. В опытах одни из них быстро или вымывались, или инактивировались, другие сохранились в течение нескольких дней.
Наибольшее количество токсических видов почвенных грибов содержат подзолистые, серо-бурые лесные и бурые таежные почвы.
Некоторые почвенные грибы вырабатывают токсины, действующие на животных и на людей.
Известно, что некоторые виды почвенных грибов образуют вещества, стимулирующие рост растений. Одни из этих веществ — гиббереллины — образует гриб из рода фузариум. Он представляет собой конидиальную стадию сумчатого гриба — гиббереллы, откуда и получили свое название вещества. Впервые они были обнаружены японским исследователем Е. Куросавой в связи с изучением болезней риса, среди которых наиболее загадочной считалась "болезнь дурных побегов", или бакане, распространенная в Японии, Китае, Индии и ряде других стран. (Междоузлия риса, пораженного этой болезнью, сильно вытягиваются, а все растение очень сильно ветвится.) Причиной заболевания риса оказался фузариум, а затем были выделены и вещества, вызывавшие симптомы заболевания. Впоследствии выяснилось, что гиббереллины способны стимулировать у различных растений не только рост побегов, листьев, в меньшей степени корней, но и ускорять цветение и плодоношение. Вещества эти, а их известно уже несколько, адсорбируются почвой и могут сохраняться в нестерильной почвенной среде физиологически активными в течение более 1,5 мес.
В последние годы гиббереллины используют, в частности, в тех случаях, когда требуется увеличить у технических культур длину стеблей, а следовательно, и волокон, ускорить цветение или выгонку семенников у декоративных растений.
Часто наблюдается задержка или угнетение прорастания спор грибов, находящихся в почве. Такое явление называется фунгистазисом и наиболее отчетливо выражено в почвах с большим количеством микроорганизмов и недостатком питательных веществ. Объясняется оно тем, что в таких почвах особенно обостряется конкуренция между обитателями почвы и активный мицелий грибов может разрушаться другими микроорганизмами. Споры в этом отношении более стойки и могут сохраняться какое-то время в состоянии покоя до тех пор, пока условия не станут более благоприятными для их прорастания. Следовательно, состояние фунгистазиса полезно для грибов. Еще лучше грибы могут переживать неблагоприятный период в почве в виде таких структур, как хламидоспоры, зиготы, склероции и т. п. Наличие таких структур особенно характерно для грибов-паразитов растений (видов из родов фузариум, вертициллиум, биполярис, склеротиния, аскохита), у которых такие структуры могут сохраняться некоторое время в почве при отсутствии восприимчивых к ним высших растений-хозяев. Таким образом, фунгистазис представляет собой вынужденный покой, возникший и закрепившийся в процессе эволюции как полезный для сохранения вида. Если искусственно прервать этот покой и вызвать прорастание покоящихся структур или спор, например до появления на поле восприимчивых растений или до развития тех стадий, на которых они восприимчивы, то таким приемом можно понизить вероятность поражения растения соответствующим паразитом. Эта же цель может быть достигнута и обратным путем, т. е. длительной задержкой прорастания покоящихся структур до тех пор, пока высшее растение-хозяин пройдет в своем развитии ту стадию, на которой оно особенно подвержено заражению паразитом, и таким образом избегнет заражения.
Почвенный гриб кератиномицес айеллои внутри волоса
Почвенные грибы участвуют в процессах почвообразования, не только разрушая различные вещества, попадающие в почву. Грибы способствуют и оструктуриванию почвы или, иначе говоря, образованию деятельного или активного перегноя. Особенно важна роль грибов, живущих в тяжелых глинистых и суглинистых почвах, так как оструктуривание их грибами увеличивает аэрируемость и улучшает снабжение их водой.
В конце XIX в. образование комочков почвы приписывалось исключительно деятельности дождевых червей, позже на первый план выступили физико-химические свойства почвы, т. е. образование почвенной структуры связывалось с действием растворимых солей кальция, магния, калия, обладающих осаждающей способностью, а затем снова возникли биологические теории структурообразования, в том числе было доказано участие в этом процессе грибов. Оказалось, что выделяемые почвенными грибами вещества как бы склеивают почвенные частички друг с другом. Этому же способствуют и сами нити грибницы, оплетающие и пронизывающие частички. Даже тогда, когда грибница отмирает, продукты ее разложения продолжают выполнять эту функцию.
Многие почвенные грибы являются хорошими структурообразователями, но, как показали опыты, особенно сильной агрегирующей способностью обладают некоторые мукоровые (виды родов мукор, ризопус, абсидия), сумчатые (виды рода хетомиум), некоторые дейтеромицеты (виды родов триходерма, аспергилл, фузариум). Часто внесение этих грибов в почву вместе со свободно живущей азотфиксирующей почвенной бактерией азотобактером хроококкум способствовало более хорошему росту бактерии, что также улучшало структуру почвы.
Деятельность грибов в почве не ограничивается, однако, теми процессами, о которых было сказано. Существует мнение, что образование и разрушение гумуса также связано с деятельностью почвенных грибов и в процессе их жизни и после гибели мицелия в окружающую среду обильно выделяются вещества, которые могут принимать участие в синтезе гумуса. В частности, некоторые аспергиллы и пенициллы, темноокрашенные дейтеромицеты выделяют пигменты и антибиотические вещества, способные соединяться с другими азотсодержащими продуктами разложения органических веществ, в том числе белками (аминокислотами, пептидами), продуктами деградации лигнина, и образовывать комплексы, сходные с гуминовыми кислотами, входящими в состав гумуса. Особое значение в этом процессе имеют как раз темные пигменты, присущие многим почвенным грибам, особенно дейтеромицетам. Оказалось, что эти пигменты (меланины) по ряду химических и физических свойств очень сходны с гуминовыми кислотами.
Некоторые почвенные грибы способны и разлагать гумус, использовать его в качестве единственного источника углерода и азота. Например, присутствующий в некоторых почвах пеницилл частый освобождает в ходе этого процесса азот, который может быть использован высшими растениями.
В состав гумуса входит фосфор — элемент, необходимый для нормального роста и развития высших растений. Грибы, в частности пенициллы, образующие органические кислоты, активно участвуют в превращении нерастворимого фосфора в растворимый и, следовательно, доступный высшим растениям.
Таким образом, почвенные грибы представляют собой чрезвычайно активную группу, принимающую важное участие в процессах почвообразования. Своими ферментами они содействуют разложению различных материалов, попадающих в почву, и переводят часть переработанных веществ в компоненты своего тела. Другие части или отлагаются в почве, меняя ее химический состав и свойства, или используются и перерабатываются другими организмами. Многие почвенные грибы воздействуют и на минеральную основу почвы органическими кислотами, которые образуются и накапливаются при разложении этими грибами различных составных частей растительных клеток. Особенно активно накопление этих кислот протекает в подзолистых лесных почвах, в которых грибы представлены многочисленными видами пенициллов. В результате этого отдельные зольные элементы переходят в растворенное состояние, происходит разложение минералов, образование комплексных соединений, перемещающихся в нижележащие слои почвы, — развивается процесс подзолообразования.
Нельзя не упомянуть и о роли почвенных грибов в токсикозе почв. Некоторые виды грибов выделяют в почву ядовитые вещества — токсины, и почва при этом часто становится токсичной для высших растений. Частый случай токсикоза почв — почвоутомление. Оно заключается в том, что растения на таких почвах угнетаются, снижают урожайность. Особенно часто это бывает, когда в течение многих лет на одном и том же месте возделывается какая-нибудь одна культура. Токсикоз почв отражается и на почвенных микроорганизмах, причем иногда это совпадает с угнетением развития высших растений. Как выяснилось, наибольшее количество токсичных видов среди пенициллов. Токсичны и некоторые виды родов триходерма, фузариум, альтернария, аспергиллы и др. Все они выделяют вещества, могущие подавлять прорастание семян растений.
Длительность сохранения токсинов в почве различна. В опытах одни из них быстро или вымывались, или инактивировались, другие сохранились в течение нескольких дней.
Наибольшее количество токсических видов почвенных грибов содержат подзолистые, серо-бурые лесные и бурые таежные почвы.
Некоторые почвенные грибы вырабатывают токсины, действующие на животных и на людей.
Известно, что некоторые виды почвенных грибов образуют вещества, стимулирующие рост растений. Одни из этих веществ — гиббереллины — образует гриб из рода фузариум. Он представляет собой конидиальную стадию сумчатого гриба — гиббереллы, откуда и получили свое название вещества. Впервые они были обнаружены японским исследователем Е. Куросавой в связи с изучением болезней риса, среди которых наиболее загадочной считалась "болезнь дурных побегов", или бакане, распространенная в Японии, Китае, Индии и ряде других стран. (Междоузлия риса, пораженного этой болезнью, сильно вытягиваются, а все растение очень сильно ветвится.) Причиной заболевания риса оказался фузариум, а затем были выделены и вещества, вызывавшие симптомы заболевания. Впоследствии выяснилось, что гиббереллины способны стимулировать у различных растений не только рост побегов, листьев, в меньшей степени корней, но и ускорять цветение и плодоношение. Вещества эти, а их известно уже несколько, адсорбируются почвой и могут сохраняться в нестерильной почвенной среде физиологически активными в течение более 1,5 мес.
В последние годы гиббереллины используют, в частности, в тех случаях, когда требуется увеличить у технических культур длину стеблей, а следовательно, и волокон, ускорить цветение или выгонку семенников у декоративных растений.
Часто наблюдается задержка или угнетение прорастания спор грибов, находящихся в почве. Такое явление называется фунгистазисом и наиболее отчетливо выражено в почвах с большим количеством микроорганизмов и недостатком питательных веществ. Объясняется оно тем, что в таких почвах особенно обостряется конкуренция между обитателями почвы и активный мицелий грибов может разрушаться другими микроорганизмами. Споры в этом отношении более стойки и могут сохраняться какое-то время в состоянии покоя до тех пор, пока условия не станут более благоприятными для их прорастания. Следовательно, состояние фунгистазиса полезно для грибов. Еще лучше грибы могут переживать неблагоприятный период в почве в виде таких структур, как хламидоспоры, зиготы, склероции и т. п. Наличие таких структур особенно характерно для грибов-паразитов растений (видов из родов фузариум, вертициллиум, биполярис, склеротиния, аскохита), у которых такие структуры могут сохраняться некоторое время в почве при отсутствии восприимчивых к ним высших растений-хозяев. Таким образом, фунгистазис представляет собой вынужденный покой, возникший и закрепившийся в процессе эволюции как полезный для сохранения вида. Если искусственно прервать этот покой и вызвать прорастание покоящихся структур или спор, например до появления на поле восприимчивых растений или до развития тех стадий, на которых они восприимчивы, то таким приемом можно понизить вероятность поражения растения соответствующим паразитом. Эта же цель может быть достигнута и обратным путем, т. е. длительной задержкой прорастания покоящихся структур до тех пор, пока высшее растение-хозяин пройдет в своем развитии ту стадию, на которой оно особенно подвержено заражению паразитом, и таким образом избегнет заражения.
Грибы ризосферы
Особое место обитания почвенных грибов — прикорневая зона растений, или ризосфера, привлекающая внимание исследователей. В 1904 г. немецкий ученый Л. Гильтнер при изучении микронаселения прикорневой зоны ряда травянистых растений обратил внимание на повышенное содержание в ней микробов в отличие от участков почвы, находящихся вдали от корней. Он высказал мнение, что это не случайное явление, а обусловленное, по-видимому, биологической активностью корней высшего растения. Зона почвы, непосредственно прилегающая к корням и отличающаяся повышенным содержанием микробов, была названа Гильтнером ризосферой. Большинство современных исследователей различают уже не одну, а три области: • поверхность корней (ризоплана); • ризосфера (область, находящаяся в непосредственном контакте с мелкими корнями); • почва, находящаяся за пределами корней. Главная масса корней растений обычно сосредоточена в поверхностном слое почвы на глубине 0-25 см или несколько большей. Известно, что и почвенные грибы обитают главным образом в верхних горизонтах почвы. Количество их в ризосфере возрастает по сравнению с почвой вне этой зоны в 5-20 раз, в зависимости от вида растения и типа почвы. В более же глубоких слоях почвы грибы концентрируются только вокруг корней растений. Причина более сильного развития грибов в ризосфере заключается прежде всего в способности корней растений выделять в почву некоторые вещества и тем самым влиять на свойства почвы и ее обитателей. Известно, что корневые системы растений выделяют различные органические вещества: сахара, кислоты, соединения азота, фосфора, ростовые вещества и т. д. В ходе исследований было подсчитано, что за весь период вегетации корни растений могут выделять до 40-50% сухой массы создаваемого ими за это время органического вещества. Органические вещества накапливаются вокруг корней и за счет отмирания корневых волосков, клеток корневого чехлика, внешних слоев коры. В ряде случаев опытным путем установлен факт непосредственного стимулирующего действия корневых выделений на грибы: споры многих почвенных грибов лучше прорастали в присутствии проростков соответствующих пород деревьев, и образующийся при этом мицелий всегда направлялся в сторону корней. И, наоборот, семена растений лучше прорастали в присутствии соответствующих грибов или в их культуральных жидкостях, скорее сбрасывали семенные оболочки, и проростки направлялись в сторону посеянных грибов. Корневые выделения различных растений отличаются друг от друга, поэтому естественно, что комплексы грибов ризосферы того или иного растения могут быть также различны. Иногда специфика ризосферы так хорошо выражена, что при высеве на питательную среду почвы, например из-под корней таких пород, как береза, дуб, сосна, ель, уже по внешнему виду всего комплекса колоний грибов, появившихся на поверхности среды, можно сразу сказать, к ризосфере какой породы они относятся. Селекционирующее действие, т. е. отбор высшими растениями грибов их ризосферы, может происходить несколькими путями. Во-первых, растение может непосредственно угнетать своими выделениями одни микроорганизмы, в том числе грибы, и, наоборот, стимулировать и привлекать другие. Во-вторых, оно может косвенно воздействовать через стимуляцию антагонистов тех грибов, которые не типичны для их ризосферы, и тем самым устранять их из нее. И, наконец, в-третьих, устранять из ризосферы антагонистов грибов, обычно здесь обитающих. Опыты с грибами ризосферы древесных пород показали, что антагонистическое действие разных грибов одной ризосферы по отношению друг к другу почти отсутствует, в то время как по отношению к грибам из ризосферы другого вида или к грибам из почвы вне ризосферы проявляется в сильной степени. Грибы, обитающие в ризосфере, могут снабжать высшее растение некоторыми элементами питания, защищать от паразитных организмов, разрушать токсические вещества, проникающие в зону корней и т. д. В культурах таких почвенных грибов, встречающихся и в ризосфере, как аспергилл черный, аспергилл рисовый, мукор гроздевидный, некоторых видов из родов ризопус, фузариум и других были обнаружены витамины (тиамин, биотин, пантотеновая и никотиновая кислоты и др.). Некоторые антибиотические вещества, продуцируемые грибами ризосферы, могут оказывать действие и на развитие наземных органов растения. Так, антибиотик гризеофульвин, который выделяется грибом пенициллом чернеющим, воспринимался растением через корни и достигал листьев. В зоне корней улучшается структура почвы и, следовательно, процессы аэрации, дыхания корней и населения ризосферы, лучше сохраняется влага, поддерживается более постоянная температура и т. п. Таким образом, очевидно, что в зоне ризосферы могут создаваться более благоприятные условия существования как для микроорганизмов, в том числе и микроскопических грибов, так и для самих растений. С другой стороны, в ризосфере могут иногда накапливаться и вредные для высшего растения организмы, что связано с состоянием самого растения и со всеми экологическими условиями. Следовательно, в ризосфере складываются очень сложные взаимосвязи, особенно многообразно выраженные у тех растений, которые имеют микоризу, в частности у многих древесных пород. Особенно большой интерес ученые разных профилей проявляли к изучению ризосферы культурных растений, так как вопрос о том, какие микроорганизмы, полезные иди вредные, поселяются в зоне их корней, связан с решением таких практически важных задач, как получение высоких и устойчивых урожаев. Мы уже отмечали, что очень часто при длительном культивировании какого-то определенного растения в его ризосфере могут постепенно накапливаться микроорганизмы, оказывающие вредоносное действие. Возьмем к примеру, хлопчатник. Эта ценная культура страдает подчас от такого заболевания, как увядание, или вилт, вызываемого почвенными грибами, в Туркмении — главным образом фузариумом остроспоровым, в Таджикистане и Узбекистане — вертициллом георгиновым. (Вертицилл георгиновый может вызывать также увядание кленов остролистного, сахарного и ясенелистного, скумпии, лоха, золотистой смородины. У пораженных растений уменьшается количество и размер листьев, ветви усыхают, отмирают корни. Древесина окрашивается в зеленовато-черные тона. Гриб заражает растение в области корневой шейки или комля, быстро распространяется и может передаваться через корни от больных деревьев к здоровым.) Почти везде хлопчатник возделывается как монокультура, поэтому в почве полей и ризосфере растений грибов — возбудителей заболевания становится все больше и больше, причем повышается и их агрессивность. Бороться с этими грибами очень трудно, так как они не утратили способности к сапротрофной жизни и даже в случае применения севооборотов могут переживать какое-то время в почве за счет переработки растительных остатков. Кроме того, для переживания неблагоприятного периода у них имеются и специальные покоящиеся структуры — хламидоспоры у фузариума остроспорового, микросклероции у вертицилла георгинового и склероции у многих других видов грибов. С изучением закономерностей распространения почвенных микроскопических грибов в ризосфере культурных растений связаны и возможности применения биологических мер борьбы с грибами — возбудителями заболеваний растений. В ризосфере некоторых экземпляров растений хлопчатника в Туркмении были обнаружены, например, аспергиллы охряный и желтый, которые в соответствующих опытах проявили себя как сильные антагонисты к возбудителю вилта — фузариуму остроспоровому. Возможно, что внесение в почву подобных антагонистов в сочетании с разработанными приемами, обеспечивающими их дальнейшее массовое развитие в ризосфере хлопчатника, будет способствовать снижению уровня заболевания. Применение соответствующих севооборотов тоже может помочь в борьбе со многими паразитами. Установлено, например, что в ризосфере люцерны, применяемой в севообороте, накапливаются бактерии — антагонисты по отношению к возбудителю вилта хлопчатника, в частности вертицилла георгинового. Многое делается и селекционерами для получения сортов растений, устойчивых к паразитам. Однако в природе непрерывно происходит изменение (эволюция) живых организмов, поэтому приходится учитывать возможность появления новых вариантов паразитов, способных поражать вновь созданные сорта. Своеобразие ризосферы дикорастущих растений, в частности древесных пород, заключается прежде всего в том, что взаимоотношения между высшим растением и микроорганизмами, обитающими в его ризосфере, складывались в ходе длительной совместной эволюции. Поэтому они носят более постоянный характер, чем в ризосфере культурных растений, где деятельность человека (меняющиеся приемы обработки, различия в составе и количестве удобрений и т. п.) накладывала свой отпечаток и вносила какие-то изменения. Вместе с тем в естественных растительных сообществах, которым свойственно разнообразие видового состава высших растений, может быть менее выражено влияние отдельных видов на состав микроорганизмов ризосферы, преобразованное во влияние всего сообщества высших растений. Лист хлопчатника, пораженного вертициллезным увяданием (1); срез стебля (2) и лист хлопчатника (3), пораженные фузариозом; пораженный проросток хлопчатника (4)
Количество и видовой состав населения ризосферы дикорастущих и культурных растений зависят от сезонов года, а также периодов вегетации и возраста этих растений. Исследования показали, что в ризосфере однолетних дубков, например, содержится грибов почти в 4 раза больше, чем в почве вне ризосферы, затем количество их постепенно увеличивается, достигая наибольших значений у деревьев в возрасте 30-50 лет. Когда же интенсивность физиологических процессов у дуба начинает падать, а почва под ним истощается, происходит снижение количества грибов в ризосфере. Эта же закономерность наблюдалась у всех других изученных пород.
Лист хлопчатника, пораженного вертициллезным увяданием (1); срез стебля (2) и лист хлопчатника (3), пораженные фузариозом; пораженный проросток хлопчатника (4)
Количество и видовой состав населения ризосферы дикорастущих и культурных растений зависят от сезонов года, а также периодов вегетации и возраста этих растений. Исследования показали, что в ризосфере однолетних дубков, например, содержится грибов почти в 4 раза больше, чем в почве вне ризосферы, затем количество их постепенно увеличивается, достигая наибольших значений у деревьев в возрасте 30-50 лет. Когда же интенсивность физиологических процессов у дуба начинает падать, а почва под ним истощается, происходит снижение количества грибов в ризосфере. Эта же закономерность наблюдалась у всех других изученных пород.
 Конидиальное спороношение (а) и микросклероции (б) вертициллиума геогинового
В ризосфере молодых деревьев обнаруживается больше грибов, обладающих антагонистическим действием, так как ризосферные комплексы здесь только формируются, происходит острая конкуренция между видами грибов — одни вытесняются другими.
Конидиальное спороношение (а) и микросклероции (б) вертициллиума геогинового
В ризосфере молодых деревьев обнаруживается больше грибов, обладающих антагонистическим действием, так как ризосферные комплексы здесь только формируются, происходит острая конкуренция между видами грибов — одни вытесняются другими.
 Конидии (а) и хламидоспоры (б) фузариума остропорового
По мере старения дерева уменьшается не только общее количество грибов в ризосфере, но и снижается количество видов, обладающих антагонистическими свойствами, сужается спектр их антибиотического действия. Вероятно это одна из причин поражаемости старых деревьев различными корневыми гнилями и другими заболеваниями.
Все, что говорилось здесь о почвенных грибах, далеко не исчерпывает их значения и роли в природе и в жизни человека. Изучение распространения, свойств и возможностей использования почвенных грибов продолжается. В настоящее время очень актуальным представляется решение такой общей задачи, как установление комплексов грибов, характеризующих определенный тип почвы, т. е. стадию процесса почвообразования. Этому вопросу посвящается очень много работ и в нашей стране и за рубежом. Почвенные грибы изучаются и как возможные индикаторы залежей полезных ископаемых. Все больше развивается экологическое направление в изучении почвенных грибов. Выясняется зависимость развития определенных видов от различных экологических факторов, изучаются экологические формы видов и их особенности, познается роль грибов как составных элементов экосистемы.
Очень важна разработка мер борьбы с вредным действием некоторых грибов. Наряду с этим развиваются исследования полезной деятельности грибов и возможного многообразного использования продуктов их жизнедеятельности (антибиотиков, ферментов, ростовых веществ и т. д.).
Конидии (а) и хламидоспоры (б) фузариума остропорового
По мере старения дерева уменьшается не только общее количество грибов в ризосфере, но и снижается количество видов, обладающих антагонистическими свойствами, сужается спектр их антибиотического действия. Вероятно это одна из причин поражаемости старых деревьев различными корневыми гнилями и другими заболеваниями.
Все, что говорилось здесь о почвенных грибах, далеко не исчерпывает их значения и роли в природе и в жизни человека. Изучение распространения, свойств и возможностей использования почвенных грибов продолжается. В настоящее время очень актуальным представляется решение такой общей задачи, как установление комплексов грибов, характеризующих определенный тип почвы, т. е. стадию процесса почвообразования. Этому вопросу посвящается очень много работ и в нашей стране и за рубежом. Почвенные грибы изучаются и как возможные индикаторы залежей полезных ископаемых. Все больше развивается экологическое направление в изучении почвенных грибов. Выясняется зависимость развития определенных видов от различных экологических факторов, изучаются экологические формы видов и их особенности, познается роль грибов как составных элементов экосистемы.
Очень важна разработка мер борьбы с вредным действием некоторых грибов. Наряду с этим развиваются исследования полезной деятельности грибов и возможного многообразного использования продуктов их жизнедеятельности (антибиотиков, ферментов, ростовых веществ и т. д.).
Микоризные грибы
Микориза и краткая история ее изучения
 В ходе совместной эволюции грибы и деревья выработали сложные взаимоотношения, при которых оба организма получают взаимную пользу
Еще в очень давние времена люди заметили, что плодовые тела некоторых грибов растут в соседстве с определенными породами деревьев, как бы привязаны к ним. Это наблюдение отразилось и в народных названиях ряда грибов — подосиновик, подберезовик, поддубовик. Более тесную связь грибов с корнями растений удалось установить, когда ученые стали широко пользоваться микроскопом. В первой половине прошлого века при исследовании срезов корней различных растений было замечено, что внутри корней имеются какие-то нитчатые образования. В некоторых случаях наблюдатели даже отмечали постоянность этого явления, однако рассматривали это как курьезы. Только в середине прошлого века было установлено, что наблюдавшиеся в корнях нити представляют собой гифы гриба. Это открытие сделал австрийский ученый С. Рейссек в 1847 г. Он пытался даже выделить из корней и культивировать мицелий, но при этом, учитывая технику того времени, конечно, выделял те грибы, которые попадали на питательную среду из почвы, окружающей корни, или из воздуха. Большинство исследователей того времени считали, что гриб паразитирует на корнях растений. Нахождение гиф гриба в корнях рассматривалось в те времена как одно из доказательств господствовавшего тогда представления о том, что грибы, как и бактерии, зарождаются из неорганических или органических веществ и могут возникать при отмирании растений и животных.
Постепенно сведения о распространенности сообщества корней растений и гиф грибов накапливались. Исследователи обратили внимание на факт, что некоторые растения, например бесцветные орхидные (гнездовка, кораллориза) и подъельник, непременно и постоянно несут в своих корнях или корневищах гифы гриба. Обращало на себя внимание и своеобразное развитие тех частей корня дерева, которые содержали в себе гифы гриба: эти части или булавовидно вздуты на концах или ветвятся необычным образом. Изучение и обнаружение двойственной природы лишайников, представляющих собой объединение гиф гриба и клеток водорослей, тоже стимулировало интерес к изучению взаимоотношений между зелеными растениями и другими организмами, в том числе и с грибами. В 1881 г. появились сначала предварительные, а в 1882 и 1886 гг. уже подробно изложенные итоги классических исследований профессора Новороссийского университета Ф. М. Каменского. В своих работах он подробно описал анатомическую картину коней подъельника, отмечая, что на корнях отсутствуют корневые волоски и чехлик, а вместо них имеется оболочка из сплетающихся грибных гиф, проникновение гиф мицелия между клетками эпидермиса и образование сети из гиф, отделяющих клетки коры одну от другой. Каменский делает заключение, что все растворимые вещества из почвы должны поступать к корням подъельника, проходя через грибную зону, и поднимает вопрос о значении этого явления для растений. Самым важным выводом из работ ученого было представление о том, что отношения между грибом корня и растением существенно отличаются от отношений обычного паразитизма.
В ходе совместной эволюции грибы и деревья выработали сложные взаимоотношения, при которых оба организма получают взаимную пользу
Еще в очень давние времена люди заметили, что плодовые тела некоторых грибов растут в соседстве с определенными породами деревьев, как бы привязаны к ним. Это наблюдение отразилось и в народных названиях ряда грибов — подосиновик, подберезовик, поддубовик. Более тесную связь грибов с корнями растений удалось установить, когда ученые стали широко пользоваться микроскопом. В первой половине прошлого века при исследовании срезов корней различных растений было замечено, что внутри корней имеются какие-то нитчатые образования. В некоторых случаях наблюдатели даже отмечали постоянность этого явления, однако рассматривали это как курьезы. Только в середине прошлого века было установлено, что наблюдавшиеся в корнях нити представляют собой гифы гриба. Это открытие сделал австрийский ученый С. Рейссек в 1847 г. Он пытался даже выделить из корней и культивировать мицелий, но при этом, учитывая технику того времени, конечно, выделял те грибы, которые попадали на питательную среду из почвы, окружающей корни, или из воздуха. Большинство исследователей того времени считали, что гриб паразитирует на корнях растений. Нахождение гиф гриба в корнях рассматривалось в те времена как одно из доказательств господствовавшего тогда представления о том, что грибы, как и бактерии, зарождаются из неорганических или органических веществ и могут возникать при отмирании растений и животных.
Постепенно сведения о распространенности сообщества корней растений и гиф грибов накапливались. Исследователи обратили внимание на факт, что некоторые растения, например бесцветные орхидные (гнездовка, кораллориза) и подъельник, непременно и постоянно несут в своих корнях или корневищах гифы гриба. Обращало на себя внимание и своеобразное развитие тех частей корня дерева, которые содержали в себе гифы гриба: эти части или булавовидно вздуты на концах или ветвятся необычным образом. Изучение и обнаружение двойственной природы лишайников, представляющих собой объединение гиф гриба и клеток водорослей, тоже стимулировало интерес к изучению взаимоотношений между зелеными растениями и другими организмами, в том числе и с грибами. В 1881 г. появились сначала предварительные, а в 1882 и 1886 гг. уже подробно изложенные итоги классических исследований профессора Новороссийского университета Ф. М. Каменского. В своих работах он подробно описал анатомическую картину коней подъельника, отмечая, что на корнях отсутствуют корневые волоски и чехлик, а вместо них имеется оболочка из сплетающихся грибных гиф, проникновение гиф мицелия между клетками эпидермиса и образование сети из гиф, отделяющих клетки коры одну от другой. Каменский делает заключение, что все растворимые вещества из почвы должны поступать к корням подъельника, проходя через грибную зону, и поднимает вопрос о значении этого явления для растений. Самым важным выводом из работ ученого было представление о том, что отношения между грибом корня и растением существенно отличаются от отношений обычного паразитизма.
 Корни подъельника с микоризой (по Ф. М. Каменскому)
В 1885 г. были опубликованы исследования профессора физиологии растений Берлинского университета А. В. Франка, который назвал наблюдавшееся им и постоянно встречавшееся соединение тканей корней деревьев и мицелия грибов микоризой (в переводе грибокорень). Франк провел аналогию между талломом лишайников и микоризой и сделал заключение, что в обоих случаях имеет место постоянный симбиоз, или сожительство, двух различных организмов. Чехол из сплетения гиф гриба с отходящими во все стороны свободными гифами действует как поглощающая система дерева, через которую проходят вода и минеральные соли на пути к сосудам дерева. Гифы внутренней части грибного чехла и гифы, образующие внутреннюю сеть, сообщаются с гифами, выходящими наружу. Такая микориза была названа эктотрофной (от греч. "эктос" — вне, снаружи, и "трофе" — питание). Франк считал, что основная роль гриба в случае микоризы деревьев заключается в том, что гриб разлагает гумус и, таким образом, доставляет дереву питательные вещества, содержащие углерод и азот, которые без деятельности гриба для него были бы недоступны. В клетках корня орхидных Франк наблюдал переваривание мицелия гриба.
Корни подъельника с микоризой (по Ф. М. Каменскому)
В 1885 г. были опубликованы исследования профессора физиологии растений Берлинского университета А. В. Франка, который назвал наблюдавшееся им и постоянно встречавшееся соединение тканей корней деревьев и мицелия грибов микоризой (в переводе грибокорень). Франк провел аналогию между талломом лишайников и микоризой и сделал заключение, что в обоих случаях имеет место постоянный симбиоз, или сожительство, двух различных организмов. Чехол из сплетения гиф гриба с отходящими во все стороны свободными гифами действует как поглощающая система дерева, через которую проходят вода и минеральные соли на пути к сосудам дерева. Гифы внутренней части грибного чехла и гифы, образующие внутреннюю сеть, сообщаются с гифами, выходящими наружу. Такая микориза была названа эктотрофной (от греч. "эктос" — вне, снаружи, и "трофе" — питание). Франк считал, что основная роль гриба в случае микоризы деревьев заключается в том, что гриб разлагает гумус и, таким образом, доставляет дереву питательные вещества, содержащие углерод и азот, которые без деятельности гриба для него были бы недоступны. В клетках корня орхидных Франк наблюдал переваривание мицелия гриба.
 Корень березы с микоризой
Работы Каменского и Франка послужили началом чрезвычайно большого количества исследований, посвященных изучению микоризы. Это и работы по анатомии и морфологии микоризы различных растений, и многообразные физиологические исследования, выясняющие интимные стороны взаимоотношений компонентов. Особенно большие успехи в деле изучения физиологии микоризы были достигнуты с применением современных методов исследований. Прежде всего стало известно, насколько широко это явление представлено в природе. Можно с определенностью сказать, что микориза имеется почти у всех покрытосеменных растений, у большинства голосеменных, у многих папоротников и мхов, очень распространена у большинства наших лесных деревьев и травянистых растений и еще более обязательна у представителей семейства орхидных. У водных растений микориза отсутствует.
Корень березы с микоризой
Работы Каменского и Франка послужили началом чрезвычайно большого количества исследований, посвященных изучению микоризы. Это и работы по анатомии и морфологии микоризы различных растений, и многообразные физиологические исследования, выясняющие интимные стороны взаимоотношений компонентов. Особенно большие успехи в деле изучения физиологии микоризы были достигнуты с применением современных методов исследований. Прежде всего стало известно, насколько широко это явление представлено в природе. Можно с определенностью сказать, что микориза имеется почти у всех покрытосеменных растений, у большинства голосеменных, у многих папоротников и мхов, очень распространена у большинства наших лесных деревьев и травянистых растений и еще более обязательна у представителей семейства орхидных. У водных растений микориза отсутствует.
 Различные микоризы: 1 — булавовидные; 2 — коралловидные; 3 — вильчатые
Однако изучение особенностей роста и развития микоризных грибов сейчас интенсивно разрабатывается за рубежом и у нас в стране в связи с другой проблемой — восстановлением лесов. Рациональное использование природных богатств, и в частности лесов, настоятельно требует широких лесовосстановительных работ, возобновления лесов там, где они были вырублены, где велась промышленная заготовка леса. Такие работы проводятся у нас в стране очень широко и уже с определенностью доказывают, что выращивание лесных пород удается значительно лучше там, где при посадке саженцев вносят одновременно и почву с грибницей с мест произрастания соответствующих видов грибов или выращенную в лабораториях грибницу.
Исследования показали, что микоризы разных групп растений очень разнообразны как по строению, так и по функциям.
Различные микоризы: 1 — булавовидные; 2 — коралловидные; 3 — вильчатые
Однако изучение особенностей роста и развития микоризных грибов сейчас интенсивно разрабатывается за рубежом и у нас в стране в связи с другой проблемой — восстановлением лесов. Рациональное использование природных богатств, и в частности лесов, настоятельно требует широких лесовосстановительных работ, возобновления лесов там, где они были вырублены, где велась промышленная заготовка леса. Такие работы проводятся у нас в стране очень широко и уже с определенностью доказывают, что выращивание лесных пород удается значительно лучше там, где при посадке саженцев вносят одновременно и почву с грибницей с мест произрастания соответствующих видов грибов или выращенную в лабораториях грибницу.
Исследования показали, что микоризы разных групп растений очень разнообразны как по строению, так и по функциям.
Микориза древесных пород
Для того чтобы нагляднее представить себе, как выглядит внешне микориза корней деревьев, необходимо сравнить вид корневых окончаний с микоризой с видом корней без нее. Корни бересклета бородавчатого, например, лишенные микоризы, скудно ветвятся и одинаковы на всем протяжении в отличие от корней пород, образующих микоризу, у которых сосущие микоризные окончания отличаются от ростовых, не микоризных. Микоризные сосущие окончания или булавовидно вздуваются на кончике у дуба, или образуют очень характерные "вилочки" и сложные комплексы их, напоминающие кораллы, у сосны, или имеют форму кисти у ели. Во всех этих случаях поверхность сосущих окончаний под действием гриба сильно увеличивается. Сделав тонкий срез через микоризное окончание корня, можно убедиться в том, что анатомическая картина бывает еще более разнообразна, т. е. чехол из грибных гиф, оплетающих корневое окончание, может быть разной толщины и окраски, быть гладким или пушистым, состоящим из так плотно переплетенных гиф, что производит впечатление настоящей ткани или, наоборот, быть рыхлым. Схемы поперечных срезов различных типов микориз: 1 — пушистая микориза сосны; 2 — гладкая микориза сосны; 3 — гладкая микориза дуба; 4 — пушистая микориза березы; а — чехол; б — сеть Гартига; в — центральный цилиндр
Бывает, что чехол состоит не из одного слоя, а из двух, отличающихся между собой окраской или строением. В различной степени может быть выражена и так называемая сеть Гартига, т. е. гифы, идущие по межклетникам и образующие в совокупности действительно нечто вроде сети. В разных случаях эта сеть может распространяться на большее или меньшее количествослоев клеток паренхимы корня. Гифы гриба проникают частично и в клетки коровой паренхимы, что особенно хорошо выражено в случае микоризы осины, березы, и частично перевариваются там. Но как бы ни была своеобразна картина внутреннего строения микоризных корней, во всех случаях видно, что гифы гриба совсем не заходят в центральный цилиндр корня и в меристему, т. е. в ту зону корневого окончания, где за счет усиленного деления клеток происходит нарастание корня. Все такие микоризы называются эктоэндотрофными, поскольку у них есть и поверхностный чехол с отходящими от него гифами, и гифы, проходящие внутри ткани корня.
Не у всех пород деревьев имеется микориза таких типов, как описано выше. У клена, например, микориза другая, т. е. гриб не образует наружного чехла, зато в клетках паренхимы можно видеть не отдельно идущие гифы, а целые клубки из гиф, часто заполняющие все пространство клетки. Такая микориза называется эндотрофной (от греч. "эндос" — внутри, и "трофе" — питание) и особенно характерна для орхидных. Внешний вид микоризных окончаний (форма, ветвление, глубина проникновения) определяются породой дерева, а строение и поверхность чехла зависят от вида гриба, образующего микоризу, причем, как выяснилось, микоризу может одновременно образовать не один, а два гриба.
Схемы поперечных срезов различных типов микориз: 1 — пушистая микориза сосны; 2 — гладкая микориза сосны; 3 — гладкая микориза дуба; 4 — пушистая микориза березы; а — чехол; б — сеть Гартига; в — центральный цилиндр
Бывает, что чехол состоит не из одного слоя, а из двух, отличающихся между собой окраской или строением. В различной степени может быть выражена и так называемая сеть Гартига, т. е. гифы, идущие по межклетникам и образующие в совокупности действительно нечто вроде сети. В разных случаях эта сеть может распространяться на большее или меньшее количествослоев клеток паренхимы корня. Гифы гриба проникают частично и в клетки коровой паренхимы, что особенно хорошо выражено в случае микоризы осины, березы, и частично перевариваются там. Но как бы ни была своеобразна картина внутреннего строения микоризных корней, во всех случаях видно, что гифы гриба совсем не заходят в центральный цилиндр корня и в меристему, т. е. в ту зону корневого окончания, где за счет усиленного деления клеток происходит нарастание корня. Все такие микоризы называются эктоэндотрофными, поскольку у них есть и поверхностный чехол с отходящими от него гифами, и гифы, проходящие внутри ткани корня.
Не у всех пород деревьев имеется микориза таких типов, как описано выше. У клена, например, микориза другая, т. е. гриб не образует наружного чехла, зато в клетках паренхимы можно видеть не отдельно идущие гифы, а целые клубки из гиф, часто заполняющие все пространство клетки. Такая микориза называется эндотрофной (от греч. "эндос" — внутри, и "трофе" — питание) и особенно характерна для орхидных. Внешний вид микоризных окончаний (форма, ветвление, глубина проникновения) определяются породой дерева, а строение и поверхность чехла зависят от вида гриба, образующего микоризу, причем, как выяснилось, микоризу может одновременно образовать не один, а два гриба.
 Колбы для выращивания сеянцев в стерильных условиях
Какие же грибы образуют микоризу и с какой породой? Решить этот вопрос было не просто. В разное время предлагались для этого разные методы, вплоть до тщательного прослеживания хода грибных гиф в почве от основания плодового тела до корневого окончания. Самым эффективным методом оказался посев в стерильных условиях определенного вида гриба в почву, на которой был выращен сеянец определенной породы дерева, т. е. когда был осуществлен синтез микоризы в условиях эксперимента. Этот метод был предложен в 1936 г. шведским ученым Е. Мелином, который воспользовался простой камерой, состоящей из двух соединенных друг с другом колб. В одной из них выращивался стерильно сеянец сосны и вносился гриб в виде мицелия, взятого из молодого плодового тела в месте перехода шляпки в ножку, а в другой находилась жидкость для необходимого увлажнения почвы. Впоследствии ученые, продолжившие работы по синтезу микоризы, внесли различные усовершенствования в строение подобного прибора, которые позволяли проводить опыты в более контролируемых условиях и в течение более длительного времени.
Колбы для выращивания сеянцев в стерильных условиях
Какие же грибы образуют микоризу и с какой породой? Решить этот вопрос было не просто. В разное время предлагались для этого разные методы, вплоть до тщательного прослеживания хода грибных гиф в почве от основания плодового тела до корневого окончания. Самым эффективным методом оказался посев в стерильных условиях определенного вида гриба в почву, на которой был выращен сеянец определенной породы дерева, т. е. когда был осуществлен синтез микоризы в условиях эксперимента. Этот метод был предложен в 1936 г. шведским ученым Е. Мелином, который воспользовался простой камерой, состоящей из двух соединенных друг с другом колб. В одной из них выращивался стерильно сеянец сосны и вносился гриб в виде мицелия, взятого из молодого плодового тела в месте перехода шляпки в ножку, а в другой находилась жидкость для необходимого увлажнения почвы. Впоследствии ученые, продолжившие работы по синтезу микоризы, внесли различные усовершенствования в строение подобного прибора, которые позволяли проводить опыты в более контролируемых условиях и в течение более длительного времени.
 Аманиты, или мухоморы, — один из обязательных микоризообразователей
При использовании метода Мелина уже к 1953 г. была экспериментально доказана связь древесных пород с 47 видами грибов из 12 родов. К настоящему времени известно, что микоризы с древесными породами могут образовывать более 600 видов грибов из таких родов, как мухоморы, рядовки, гигрофоры, некоторые млечники (например, грузди), сыроежки и др., причем выяснилось, что каждый может образовать микоризу не с одной, а с различными породами деревьев. В этом отношении все рекорды побил сумчатый гриб, имеющий склероции, ценококкум зерновидный, который в условиях эксперимента образовывал микоризу с 55 видами древесных пород. Наибольшей специализацией характеризуется подлиственничный масленок, образующий микоризу с лиственницей и с кедровой сосной.
Некоторые роды грибов не способны образовывать микоризу — говорушки, коллибии, омфалия и др.
Аманиты, или мухоморы, — один из обязательных микоризообразователей
При использовании метода Мелина уже к 1953 г. была экспериментально доказана связь древесных пород с 47 видами грибов из 12 родов. К настоящему времени известно, что микоризы с древесными породами могут образовывать более 600 видов грибов из таких родов, как мухоморы, рядовки, гигрофоры, некоторые млечники (например, грузди), сыроежки и др., причем выяснилось, что каждый может образовать микоризу не с одной, а с различными породами деревьев. В этом отношении все рекорды побил сумчатый гриб, имеющий склероции, ценококкум зерновидный, который в условиях эксперимента образовывал микоризу с 55 видами древесных пород. Наибольшей специализацией характеризуется подлиственничный масленок, образующий микоризу с лиственницей и с кедровой сосной.
Некоторые роды грибов не способны образовывать микоризу — говорушки, коллибии, омфалия и др.
 Корень сосны с простыми, вильчатыми и коралловидными микоризами
И все же, несмотря на такую широкую специализацию, воздействие разных грибов-микоризообразователей на высшее растение неодинаково. Так, в микоризе сосны обыкновенной, образованной масленком, поглощение фосфора из труднодоступных соединений происходит лучше, чем тогда, когда в образовании микоризы участвует мухомор. Имеются и другие факты, которые это подтверждают. Это очень важно учитывать в практике и при приеме микоризации древесных пород для их лучшего развития следует подбирать такой гриб для той или иной породы, который бы оказывал на нее наиболее благоприятное воздействие.
Корень сосны с простыми, вильчатыми и коралловидными микоризами
И все же, несмотря на такую широкую специализацию, воздействие разных грибов-микоризообразователей на высшее растение неодинаково. Так, в микоризе сосны обыкновенной, образованной масленком, поглощение фосфора из труднодоступных соединений происходит лучше, чем тогда, когда в образовании микоризы участвует мухомор. Имеются и другие факты, которые это подтверждают. Это очень важно учитывать в практике и при приеме микоризации древесных пород для их лучшего развития следует подбирать такой гриб для той или иной породы, который бы оказывал на нее наиболее благоприятное воздействие.
 Масленок лиственный и его 'хозяева': лиственница и сосна кедровая
Теперь установлено, что гименомицеты-микоризообразователи в естественных условиях без связи с корнями деревьев не образуют плодовых тел, хотя мицелий их может существовать сапротрофно. Именно поэтому до настоящего времени на грядках нельзя было вырастить грузди, рыжики, белый гриб, подосиновик и другие ценные виды съедобных грибов. Однако в принципе это возможно. Когда-нибудь, даже в недалеком будущем, люди научатся давать мицелию все то, что он получает от сожительства с корнями деревьев, и заставят его плодоносить. Во всяком случае в лабораторных условиях такие опыты ведутся.
Масленок лиственный и его 'хозяева': лиственница и сосна кедровая
Теперь установлено, что гименомицеты-микоризообразователи в естественных условиях без связи с корнями деревьев не образуют плодовых тел, хотя мицелий их может существовать сапротрофно. Именно поэтому до настоящего времени на грядках нельзя было вырастить грузди, рыжики, белый гриб, подосиновик и другие ценные виды съедобных грибов. Однако в принципе это возможно. Когда-нибудь, даже в недалеком будущем, люди научатся давать мицелию все то, что он получает от сожительства с корнями деревьев, и заставят его плодоносить. Во всяком случае в лабораторных условиях такие опыты ведутся.
 Эктоэндотрофная микориза дуба: а — чехол; б — внутриклеточная гифа гриба. Эндотрофная микориза клена; гифы гриба и везикулы внутри клеток
Что касается древесных пород, то в высокой степени микотрофными считаются ель, сосна, лиственница, пихта, возможно, большинство и других хвойных, а из лиственных пород — дуб, бук и граб. Слабо микотрофны береза, вяз, лещина, осина, тополь, липа, ивы, ольха, рябина, черемуха. Эти породы деревьев имеют микоризу в типично лесных условиях, а в парках, садах и когда растут в виде отдельных растений могут ее и не иметь. У таких быстрорастущих пород, как тополь и эвкалипт, отсутствие микоризы часто связано с быстрым потреблением ими образующихся углеводов при интенсивном росте, т. е. углеводы не успевают накапливаться в корнях, что является необходимым условием для поселения на них гриба и образования микоризы.
Эктоэндотрофная микориза дуба: а — чехол; б — внутриклеточная гифа гриба. Эндотрофная микориза клена; гифы гриба и везикулы внутри клеток
Что касается древесных пород, то в высокой степени микотрофными считаются ель, сосна, лиственница, пихта, возможно, большинство и других хвойных, а из лиственных пород — дуб, бук и граб. Слабо микотрофны береза, вяз, лещина, осина, тополь, липа, ивы, ольха, рябина, черемуха. Эти породы деревьев имеют микоризу в типично лесных условиях, а в парках, садах и когда растут в виде отдельных растений могут ее и не иметь. У таких быстрорастущих пород, как тополь и эвкалипт, отсутствие микоризы часто связано с быстрым потреблением ими образующихся углеводов при интенсивном росте, т. е. углеводы не успевают накапливаться в корнях, что является необходимым условием для поселения на них гриба и образования микоризы.
 Схема среза эктоэндотрофной микоризы березы: а — чехол; б — внутриклеточные гифы гриба; в — переваривание гиф в клетках корня
Каковы же взаимоотношения компонентов в микоризе? Одна из первых гипотез о сущности микоризообразования была предложена в 1900 г. немецким биологом Е. Шталем. Она заключалась в следующем: в почве происходит ожесточенная конкуренция между различными организмами в борьбе за воду и минеральные соли. Особенно сильно она выражена у корней высших растений и мицелия грибов в гумусовых почвах, где грибов обычно много. Те растения, которые обладали мощной корневой системой и хорошей транспирацией, не сильно страдали в условиях такой конкуренции, а те, у которых корневая система была сравнительно слабой, а транспирация пониженной, т. е. растения, не способные успешно насасывать почвенные растворы, вышли из затруднительного положения, образовав микоризу с мощно развитой системой гиф, пронизывающих почву и повышающих поглощающую способность корня. Самое уязвимое место этой гипотезы заключается в том, что не существует прямой зависимости между всасыванием воды и поглощением минеральных солей. Таким образом, быстро поглощающие и быстро испаряющие воду растения не являются самыми вооруженными в конкурентной борьбе за минеральные соли.
Другие гипотезы основывались на способности грибов воздействовать своими ферментами на лигнино-протеиновые комплексы почвы, разрушать их и делать доступными для высших растений. Высказывались также предположения, подтвердившиеся и в дальнейшем, о том, что гриб и растение могут обмениваться ростовыми веществами, витаминами. Грибы как гетеротрофные организмы, нуждающиеся в готовом органическом веществе, получают от высшего растения прежде всего углеводы. Это подтверждалось не только опытами, но и непосредственными наблюдениями. Например, если в лесу деревья растут в сильно затененных местах, степень микоризообразования у них сильно снижена, так как в корнях не успевают накапливаться в должном количестве углеводы. Это же касается и быстрорастущих пород деревьев. Следовательно, в разреженных лесонасаждениях микориза образуется лучше, быстрее и обильнее, а поэтому процесс микоризообразования может улучшаться при проведении рубок ухода.
Введение шведскими учеными Е. Мелином и X. Нильсоном в исследования микоризы метода изотопов дало очень ценные материалы относительно значения микоризообразования для древесных пород. Была выяснена непосредственная передача к дереву через грибные гифы таких важнейших элементов, как фосфор, азот, калий, натрий, кальций и др. У сосны веймутовой, например, наличие микоризы повышало количество поглощенного калия на 75%, азота на 86, а фосфора на 234%. Применение метода изотопов позволило установить, что через грибные гифы, протягивающиеся от одних корней к другим и от одного дерева к другому в пределах одной экосистемы, происходит обмен органическими веществами между отдельными растениями. В дальнейшем было установлено, что некоторые микоризные грибы могут защищать своих партнеров от поражения паразитическими грибами, образуя антибиотики. Некоторые грибы-микоризообразователи оказались способными вызывать у своих партнеров (высших растений) образование так называемых фитоалексинов, повышающих защитные реакции.
Положительное значение микоризы древесных пород, таким образом, очевидно. Этим объясняется то внимание, которое придавалось обеспечению образования микоризы при создании лесополос в засушливых условиях степей юго-востока нашей страны, особенно у основной и главной породы лесополос — дуба. Анализ многочисленных работ, касающихся микоризы, дал возможность сделать важное заключение, что инфекционный материал (гриб) находится на поверхности самих желудей и нужно только на первых порах использовать необходимые приемы ухода за посадками (рыхление, полив и т. п.), чтобы успешно развилась микориза. Очень хорошо показало себя внесение в посадки микоризной земли совместно с культурой свободно живущей азотфиксирующей бактерии (азотобактером хроококкумом). Теперь на месте лесных полос, которые создавались в конце 40-х — начале 50-х годов, шумят листвой настоящие леса, в которых можно собирать грибы, так же, как и в лесах таежной зоны, где они издавна родились в изобилии. Однако, учитывая положительное значение микоризы древесных пород, нельзя забывать о том, что в случаях, когда почему-либо один из компонентов этого сообщества ослабляется, другой может стать агрессивным. Так, если дерево ослаблено, то наличие гриба может ослабить его еще больше и может развиться явление паразитизма гриба на корнях. Если же гриб ослаб, начинается усиленное переваривание гиф внутри корня. Таким образом, это сообщество следует рассматривать не как простой симбиоз, а как некое динамическое равновесие, т. е. равновесие в борьбе или, иными словами, как сбалансированный обоюдный паразитизм, или аллелопаразитизм (от греч. "аллелон" — друг друга, обоюдно, взаимно).
Схема среза эктоэндотрофной микоризы березы: а — чехол; б — внутриклеточные гифы гриба; в — переваривание гиф в клетках корня
Каковы же взаимоотношения компонентов в микоризе? Одна из первых гипотез о сущности микоризообразования была предложена в 1900 г. немецким биологом Е. Шталем. Она заключалась в следующем: в почве происходит ожесточенная конкуренция между различными организмами в борьбе за воду и минеральные соли. Особенно сильно она выражена у корней высших растений и мицелия грибов в гумусовых почвах, где грибов обычно много. Те растения, которые обладали мощной корневой системой и хорошей транспирацией, не сильно страдали в условиях такой конкуренции, а те, у которых корневая система была сравнительно слабой, а транспирация пониженной, т. е. растения, не способные успешно насасывать почвенные растворы, вышли из затруднительного положения, образовав микоризу с мощно развитой системой гиф, пронизывающих почву и повышающих поглощающую способность корня. Самое уязвимое место этой гипотезы заключается в том, что не существует прямой зависимости между всасыванием воды и поглощением минеральных солей. Таким образом, быстро поглощающие и быстро испаряющие воду растения не являются самыми вооруженными в конкурентной борьбе за минеральные соли.
Другие гипотезы основывались на способности грибов воздействовать своими ферментами на лигнино-протеиновые комплексы почвы, разрушать их и делать доступными для высших растений. Высказывались также предположения, подтвердившиеся и в дальнейшем, о том, что гриб и растение могут обмениваться ростовыми веществами, витаминами. Грибы как гетеротрофные организмы, нуждающиеся в готовом органическом веществе, получают от высшего растения прежде всего углеводы. Это подтверждалось не только опытами, но и непосредственными наблюдениями. Например, если в лесу деревья растут в сильно затененных местах, степень микоризообразования у них сильно снижена, так как в корнях не успевают накапливаться в должном количестве углеводы. Это же касается и быстрорастущих пород деревьев. Следовательно, в разреженных лесонасаждениях микориза образуется лучше, быстрее и обильнее, а поэтому процесс микоризообразования может улучшаться при проведении рубок ухода.
Введение шведскими учеными Е. Мелином и X. Нильсоном в исследования микоризы метода изотопов дало очень ценные материалы относительно значения микоризообразования для древесных пород. Была выяснена непосредственная передача к дереву через грибные гифы таких важнейших элементов, как фосфор, азот, калий, натрий, кальций и др. У сосны веймутовой, например, наличие микоризы повышало количество поглощенного калия на 75%, азота на 86, а фосфора на 234%. Применение метода изотопов позволило установить, что через грибные гифы, протягивающиеся от одних корней к другим и от одного дерева к другому в пределах одной экосистемы, происходит обмен органическими веществами между отдельными растениями. В дальнейшем было установлено, что некоторые микоризные грибы могут защищать своих партнеров от поражения паразитическими грибами, образуя антибиотики. Некоторые грибы-микоризообразователи оказались способными вызывать у своих партнеров (высших растений) образование так называемых фитоалексинов, повышающих защитные реакции.
Положительное значение микоризы древесных пород, таким образом, очевидно. Этим объясняется то внимание, которое придавалось обеспечению образования микоризы при создании лесополос в засушливых условиях степей юго-востока нашей страны, особенно у основной и главной породы лесополос — дуба. Анализ многочисленных работ, касающихся микоризы, дал возможность сделать важное заключение, что инфекционный материал (гриб) находится на поверхности самих желудей и нужно только на первых порах использовать необходимые приемы ухода за посадками (рыхление, полив и т. п.), чтобы успешно развилась микориза. Очень хорошо показало себя внесение в посадки микоризной земли совместно с культурой свободно живущей азотфиксирующей бактерии (азотобактером хроококкумом). Теперь на месте лесных полос, которые создавались в конце 40-х — начале 50-х годов, шумят листвой настоящие леса, в которых можно собирать грибы, так же, как и в лесах таежной зоны, где они издавна родились в изобилии. Однако, учитывая положительное значение микоризы древесных пород, нельзя забывать о том, что в случаях, когда почему-либо один из компонентов этого сообщества ослабляется, другой может стать агрессивным. Так, если дерево ослаблено, то наличие гриба может ослабить его еще больше и может развиться явление паразитизма гриба на корнях. Если же гриб ослаб, начинается усиленное переваривание гиф внутри корня. Таким образом, это сообщество следует рассматривать не как простой симбиоз, а как некое динамическое равновесие, т. е. равновесие в борьбе или, иными словами, как сбалансированный обоюдный паразитизм, или аллелопаразитизм (от греч. "аллелон" — друг друга, обоюдно, взаимно).
Микориза орхидных
 Четырехмесячный зародыш орхидеи одонтоглоссум с клубками гиф (по Н. Бернару)
Эндотрофная микориза орхидных растений характеризуется распространением гриба главным образом внутри ткани растения (в клетках паренхимы корня). Корни при этом сохраняют корневые волоски. Экспериментальные работы французского ботаника Ноэля Бернара в конце прошлого и начале нашего столетия (1899-1909 гг.) по микоризе орхидных положили начало физиологическим исследованиям микоризы не только орхидных, но и микоризы вообще. Сущность этих работ была в следующем: он стерилизовал семена орхидных и пытался прорастить их в стерильных условиях без гриба. Такие семена оставались без изменения в течение 2 мес, в то время как в контроле (без стерилизации) семена успешно прорастали и проростки содержали гифы гриба. Проросшие семена Бернар переносил в пробирки на питательную среду, где мицелий разрастался, а затем этим мицелием были заражены стерильные семена, которые после этого тоже успешно проросли. Такой же эффект получался при заражении семян мицелием, выделенным из старых корней. Ноэль Бернар изучил выделенные грибы в чистой культуре и отнес их к роду ризоктония.
Четырехмесячный зародыш орхидеи одонтоглоссум с клубками гиф (по Н. Бернару)
Эндотрофная микориза орхидных растений характеризуется распространением гриба главным образом внутри ткани растения (в клетках паренхимы корня). Корни при этом сохраняют корневые волоски. Экспериментальные работы французского ботаника Ноэля Бернара в конце прошлого и начале нашего столетия (1899-1909 гг.) по микоризе орхидных положили начало физиологическим исследованиям микоризы не только орхидных, но и микоризы вообще. Сущность этих работ была в следующем: он стерилизовал семена орхидных и пытался прорастить их в стерильных условиях без гриба. Такие семена оставались без изменения в течение 2 мес, в то время как в контроле (без стерилизации) семена успешно прорастали и проростки содержали гифы гриба. Проросшие семена Бернар переносил в пробирки на питательную среду, где мицелий разрастался, а затем этим мицелием были заражены стерильные семена, которые после этого тоже успешно проросли. Такой же эффект получался при заражении семян мицелием, выделенным из старых корней. Ноэль Бернар изучил выделенные грибы в чистой культуре и отнес их к роду ризоктония.
 Тропическая орхидея — растение с очень оригинальными и красивыми цветками. Высокая коммерческая стоимость орхидеи послужила причиной интенсивного изучения процесса микоризообразования
Семена орхидных чрезвычайно мелки и содержат ничтожно малые количества питательных веществ, недостаточных для того, чтобы обеспечить развитие растения на первых порах. Таким образом, гриб, всегда присутствующий в семенах, обеспечивает растение необходимым питанием, т. е. вначале растение паразитирует на грибе. Есть бесцветные орхидеи, например гнездовка, которые в течение всей жизни питаются с помощью гриба. Правда, в последующем было выяснено, что при достаточном питании, в частности при обеспечении среды, на которой проращиваются семена орхидных, сахарами, зародыш может развиваться и без гриба. Кстати, не только орхидные, а многолетние заростки плаунов и некоторых других растений, развивающиеся подземно и не имеющие хлорофилла, также паразитируют на грибе, содержащемся в их клетках.
Тропическая орхидея — растение с очень оригинальными и красивыми цветками. Высокая коммерческая стоимость орхидеи послужила причиной интенсивного изучения процесса микоризообразования
Семена орхидных чрезвычайно мелки и содержат ничтожно малые количества питательных веществ, недостаточных для того, чтобы обеспечить развитие растения на первых порах. Таким образом, гриб, всегда присутствующий в семенах, обеспечивает растение необходимым питанием, т. е. вначале растение паразитирует на грибе. Есть бесцветные орхидеи, например гнездовка, которые в течение всей жизни питаются с помощью гриба. Правда, в последующем было выяснено, что при достаточном питании, в частности при обеспечении среды, на которой проращиваются семена орхидных, сахарами, зародыш может развиваться и без гриба. Кстати, не только орхидные, а многолетние заростки плаунов и некоторых других растений, развивающиеся подземно и не имеющие хлорофилла, также паразитируют на грибе, содержащемся в их клетках.
 Орхидея наших широт — любка двулистная и ятрышник. Этот редкий вид охраняется законом
В наших лесах есть орхидные, у которых микориза развита очень хорошо, например любка двулистная, ятрышник пятнистый и др.
Орхидея наших широт — любка двулистная и ятрышник. Этот редкий вид охраняется законом
В наших лесах есть орхидные, у которых микориза развита очень хорошо, например любка двулистная, ятрышник пятнистый и др.
 Фукса — не уступает по красоте и изяществу своим экзотическим родственникам. Этот редкий вид охраняется законом
Гриб орхидных развивается в виде клубочков в клетках первичной коры корней и корневищ. Механизм образования этих клубочков таков: когда гифа проникает в клетку, на ее кончике появляется капелька, в которую гифа начинает врастать, но так как поверхностное натяжение этой капельки мешает гифе выйти за ее пределы, она начинает спирально закручиваться и внутри капельки образуется клубочек. Клубочки грибных гиф кормят растение, т. е. происходит их постепенное переваривание. Иногда, если зародыш, появившийся из семени, почему-либо ослаблен, гифы гриба идут по прямой через его ткань, пронизывая ее, и зародыш гибнет. Следовательно, и для микоризы орхидных тоже характерно некоторое подвижное равновесие между компонентами.
Фукса — не уступает по красоте и изяществу своим экзотическим родственникам. Этот редкий вид охраняется законом
Гриб орхидных развивается в виде клубочков в клетках первичной коры корней и корневищ. Механизм образования этих клубочков таков: когда гифа проникает в клетку, на ее кончике появляется капелька, в которую гифа начинает врастать, но так как поверхностное натяжение этой капельки мешает гифе выйти за ее пределы, она начинает спирально закручиваться и внутри капельки образуется клубочек. Клубочки грибных гиф кормят растение, т. е. происходит их постепенное переваривание. Иногда, если зародыш, появившийся из семени, почему-либо ослаблен, гифы гриба идут по прямой через его ткань, пронизывая ее, и зародыш гибнет. Следовательно, и для микоризы орхидных тоже характерно некоторое подвижное равновесие между компонентами.
 Микориза ятрышника пятнистого. Коммуникационные гифы в корневом волоске (стрелки указывают на перегородки)
Большую роль в питании орхидей играют так называемые коммуникационные гифы гриба, которые выходят в почву через корневые волоски. Было подсчитано, что у орхидеи любки зеленоцветковой на одном корне, а в среднем их 5-7, имелось 1693 корневых волоска с гифами и из каждого выходило в среднем по 3 гифы, таким образом, общее число гиф, выходящих из корней, было примерно 33 000. Таким образом, всасывающая поверхность растения сильно увеличивается, и грибные гифы доставляют растению воду, могут снабжать его азотом и другими необходимыми веществами.
Микориза ятрышника пятнистого. Коммуникационные гифы в корневом волоске (стрелки указывают на перегородки)
Большую роль в питании орхидей играют так называемые коммуникационные гифы гриба, которые выходят в почву через корневые волоски. Было подсчитано, что у орхидеи любки зеленоцветковой на одном корне, а в среднем их 5-7, имелось 1693 корневых волоска с гифами и из каждого выходило в среднем по 3 гифы, таким образом, общее число гиф, выходящих из корней, было примерно 33 000. Таким образом, всасывающая поверхность растения сильно увеличивается, и грибные гифы доставляют растению воду, могут снабжать его азотом и другими необходимыми веществами.
 Микоза любки двулистной (клубки гиф в клетках корня)
Микоризу с орхидными образуют главным образом различные виды базидиаль-ных грибов (гименомицетов) — осенний опенок, негниючники, кортициум и др. Один и тот же гриб может образовать микоризу с несколькими видами орхидных, и, наоборот, у одной орхидеи в качестве грибного компонента может быть несколько видов.
Микоза любки двулистной (клубки гиф в клетках корня)
Микоризу с орхидными образуют главным образом различные виды базидиаль-ных грибов (гименомицетов) — осенний опенок, негниючники, кортициум и др. Один и тот же гриб может образовать микоризу с несколькими видами орхидных, и, наоборот, у одной орхидеи в качестве грибного компонента может быть несколько видов.
 Микориза ятрышника пятнистого (стрелка указывает на клетку с полупереваренными гифами)
Изучение микоризы орхидных привело Бернара к предположению, что образование у растений клубней, луковиц, корневищ представляет собой результат поселения в них гриба, так как гриб своим присутствием вызывает превращение крахмала в растворимые сахара (концентрация клеточного сока, таким образом, повышается, возникает давление на оболочки, и клетки разбухают).
В последние годы у микоризообразую-щих грибов были открыты физиологически активные вещества кинины, регулирующие ростовые процессы и, в частности, стимулирующие деление клеток растений, что могло также сыграть свою роль в образовании клубней и луковиц.
Микориза ятрышника пятнистого (стрелка указывает на клетку с полупереваренными гифами)
Изучение микоризы орхидных привело Бернара к предположению, что образование у растений клубней, луковиц, корневищ представляет собой результат поселения в них гриба, так как гриб своим присутствием вызывает превращение крахмала в растворимые сахара (концентрация клеточного сока, таким образом, повышается, возникает давление на оболочки, и клетки разбухают).
В последние годы у микоризообразую-щих грибов были открыты физиологически активные вещества кинины, регулирующие ростовые процессы и, в частности, стимулирующие деление клеток растений, что могло также сыграть свою роль в образовании клубней и луковиц.
Эндотрофная микориза травянистых и некоторых древесных растений
Этот тип микоризы наиболее распространен: примерно 70, а в некоторых местообитаниях 90% всех растений имеют такую микоризу. Особенности ее в том, что внешний вид корня не меняется. На срезах же видно, что гифы гриба в корне не имеют перегородок (мицелий неклеточный), обильно ветвятся, а на кончиках гиф или на их протяжении образуются вздутия, пузырьки, или везикулы, вначале содержащие много вакуолей, а затем — зернистую массу цитоплазмы и капельки жира. По-видимому, они служат для запасания питательных веществ. Характерно также образование, правда, не у всех растений, так называемых арбускул. Это ответвления гиф, посылаемые в клетку. Они тоньше, чем мицелий, от которого они отходят, и многократно дихотомически ветвятся, напоминая собой деревце. Одни исследователи считают арбускулы органами всасывания, при помощи которых гриб получает питание из клетки, другие рассматривают их как результат воздействия клетки хозяина на внедрение гриба так как в дальнейшем арбускулы начиная с кончика постепенно перевариваются (иногда даже оболочка кончика разрывается и содержимое поступает в клетку). У многих растений, имеющих такую (арбускулярно-везикулярную) микоризу, например у земляники, яблони, томатов, салата, некоторых злаковых растений, грибной компонент относится к роду эндо-гоне из зигомицетов. Имеются сведения, что виды этого же рода могут образовать микоризу и с древесными породами, например с сосной, псевдотсугой. У некоторых видов лука, заростков некоторых папоротников и других растений находят гриб питиум, переходящий затем и на взрослое растение. Указывают и другие роды и виды грибов. Есть данные, что микоризные растения скорее и успешнее накапливают необходимые элементы, например фосфор, по сравнению с немикоризными. Арбускулярно-везикулярная микориза обычно рассматривается как состояние хронической неопасной или терпимой инфекции растения-хозяина. Арбускула (разветвление мицелия) в клетках корня лука круглоголового; местами происходит переваривание веточек арбускулы
Гриб мало патогенен, а растение-хозяин также не может полностью уничтожить его, так как в ряде клеток он не переваривается.
У многих растений, в частности у пшеницы, проса, кукурузы и др., в клетках первичной коры корней также обнаруживается присутствие гиф уже многоклеточного мицелия, вначале в виде клубочков из гиф, которые обычно растворяются под действием растения-хозяина, особенно в период его цветения. В некоторых случаях оказывалось, что гриб принадлежал к видам рода фузариум. При искусственном заражении таким грибом проростков пшеницы выяснилось, что поведение гриба определялось условиями окружающей среды. Если почва сильно увлажнена, гриб проникает в центральный цилиндр корня, вызывая его побурение, закупорку и разрушение клеток, т. е. ведет себя как опасный паразит, а если влажность почвы невелика, растения часто развиваются намного лучше контрольных (без гриба)! Следовательно, и те почвенные грибы, которые могут вести себя как сапротрофы и как паразиты, в определенных условиях бывают и полезными: энергично разрушают дернину, дают дополнительное питание растению, подвергаясь перевариванию в клетках его корней.
Арбускула (разветвление мицелия) в клетках корня лука круглоголового; местами происходит переваривание веточек арбускулы
Гриб мало патогенен, а растение-хозяин также не может полностью уничтожить его, так как в ряде клеток он не переваривается.
У многих растений, в частности у пшеницы, проса, кукурузы и др., в клетках первичной коры корней также обнаруживается присутствие гиф уже многоклеточного мицелия, вначале в виде клубочков из гиф, которые обычно растворяются под действием растения-хозяина, особенно в период его цветения. В некоторых случаях оказывалось, что гриб принадлежал к видам рода фузариум. При искусственном заражении таким грибом проростков пшеницы выяснилось, что поведение гриба определялось условиями окружающей среды. Если почва сильно увлажнена, гриб проникает в центральный цилиндр корня, вызывая его побурение, закупорку и разрушение клеток, т. е. ведет себя как опасный паразит, а если влажность почвы невелика, растения часто развиваются намного лучше контрольных (без гриба)! Следовательно, и те почвенные грибы, которые могут вести себя как сапротрофы и как паразиты, в определенных условиях бывают и полезными: энергично разрушают дернину, дают дополнительное питание растению, подвергаясь перевариванию в клетках его корней.
 Эндотрофная микориза пелии налистной (вздутия мицелия — везикулы в клетках корня)
Эффект взаимоотношений компонентов в данном случае зависит от условий, следовательно, возможно направить этот процесс в нужную сторону, что может иметь большое практическое значение.
Очень много специальных работ посвящено эндотрофной микоризе вересковых, к которым относится вереск, багульник, рододендрон, брусника и др. Семена этих растений обычно содержат гриб в своих покровах, и вначале у этих растений предполагался обязательный, или облигатный, характер микориз, как и у орхидных. Позже выяснилось, что при достаточном снабжении питательными веществами (сахарами) растения могут развиваться и без гриба. Однако полезность для них гриба очевидна, если учесть, что многие вересковые развиваются на торфяниках — кислых почвах, бедных легкоусвояемыми соединениями азота (нитратами). Было даже высказано предположение, подтверждавшееся опытами, что грибы микоризы вересковых способны усваивать атмосферный азот.
Эндотрофная микориза пелии налистной (вздутия мицелия — везикулы в клетках корня)
Эффект взаимоотношений компонентов в данном случае зависит от условий, следовательно, возможно направить этот процесс в нужную сторону, что может иметь большое практическое значение.
Очень много специальных работ посвящено эндотрофной микоризе вересковых, к которым относится вереск, багульник, рододендрон, брусника и др. Семена этих растений обычно содержат гриб в своих покровах, и вначале у этих растений предполагался обязательный, или облигатный, характер микориз, как и у орхидных. Позже выяснилось, что при достаточном снабжении питательными веществами (сахарами) растения могут развиваться и без гриба. Однако полезность для них гриба очевидна, если учесть, что многие вересковые развиваются на торфяниках — кислых почвах, бедных легкоусвояемыми соединениями азота (нитратами). Было даже высказано предположение, подтверждавшееся опытами, что грибы микоризы вересковых способны усваивать атмосферный азот.
 Вереск — растение, имеющее микоризу. По словам исследовательницы микоризы вересковых М. Райнер, 'растения почв, бедных нитратами (азотом), разрешили проблему жизни на этих почвах ценой своей независимости'
Ферменты грибов в случае микоризы вересковых играют, по-видимому, большую роль в разложении сложных азото-содержащих соединений, не доступных иначе растениям. Многие авторы указывают на то, что между растениями, живущими на почвах, бедных легкоусвояемыми соединениями азота, происходит особенно ожесточенная борьба за источники азота. В ходе этой борьбы выработались такие замечательные приспособления, как насе-комоядность, например у росянки — жительницы болот, или сожительство с азот-фиксирующими бактериями у некоторых других растений. Очевидно, нечто подобное можно сказать и о сожительстве растений с грибами.
По данным многих авторов, грибы, сожительствующие с вересковыми, могут уменьшать вредное воздействие на эти растения торфяных почв. К грибам, образующим микоризу вересковых, относятся виды рода питиум из оомицетов, мортие-реллы из зигомицетов, пецицеллы из сумчатых, клаварии из базидиомицетов, фома из дейтеромицетов, т. е. представители почти всех классов грибов.
Некоторые растения имеют микоризу как бы промежуточного типа между экто-трофной и эндотрофной. Например, виды семейства грушанковых, у которых корневые окончания не имеют корневых волосков, окружены грибным чехлом, имеют сеть Гартига и содержат клубки гиф в клетках эпидермиса. Одна из грушанок Северной Америки, не имеющая листьев, паразитирует на своем грибе.
Ископаемые остатки показывают, что древнейшие высшие растения каменноугольного и девонского периодов палеозойской эры уже имели микоризу. Формирование ее происходило, по-видимому, так, что первоначально гриб начинал паразитировать на растении, стремясь уйти от конкуренции с почвенными сапротрофными микроорганизмами, но высшее растение защищалось, и впоследствии установились более или менее сбалансированные отношения. В одних случаях закрепился односторонний хронический, не сильно вредящий паразитизм гриба на высшем растении (многие арбускулярно-везикулярные эндотрофные микоризы), в других — аллело-паразитизм (микоризы древесных пород, зеленых орхидей), в третьих — паразитизм высшего растения на грибе (бесхлорофил-льные орхидеи, заростки плауновых и др.).
В последние годы возникло еще одно очень важное и перспективное направление в изучении как почвенных микроскопических грибов, так и вопросов, связанных с микоризообразованием. Дело в том, что в связи с высокими и непрерывно растущими темпами развития промышленности и добычи полезных ископаемых большие территории земной поверхности оказываются нарушенными. Например, в тех местах, где ведется подземная добыча полезных ископаемых, породы, покрывающие поверхность земли, проседают, образуя углубления рельефа, на месте которых иногда развиваются болота. Кроме того, на таких просадках обычно образуются разрывы корней деревьев и деревья погибают. Отвалы после разработок также уменьшают полезную поверхность земли, часто содержат токсические вещества, загрязняют воздух.
Возвращение нарушенных земель в хозяйственное использование имеет первостепенное значение. На отвалах, старых выработках, шахтах, местах добычи торфа и тому подобных неудобных землях часто выращивают леса и парки. Такая практика сложилась уже в большинстве стран. Для каждого региона при этом требуется разработка соответствующей системы мероприятий со строгим учетом всех факторов среды и подбор определенных пород деревьев и кустарников.
Если учесть все то, что было сказано о роли грибов в процессах почвообразования, становится ясным их значение, например, в деле превращения горных пород в первичную почву, т. е. в разрушении минералов и образовании соединений, способных усваиваться растениями, в оструктури-вании почвы, трансформации органических остатков, формировании гумуса, разрушении токсических веществ и т. д.
Велико значение грибов и как микоризо-образователей, так как развитие микоризы может обеспечить и хорошее развитие соответствующих пород. В отвалах практически отсутствуют доступные для растений азотные соединения, но такая, например, порода, как береза, или хвойные могут обеспечить себя этими соединениями, образуя микоризу. В ряде случаев, особенно в посадках сосны на отвалах, наблюдалось обильное развитие микоризы, которое сопровождалось улучшением роста деревьев. Вскоре в таких посадках появлялись и плодовые тела грибов.
Вереск — растение, имеющее микоризу. По словам исследовательницы микоризы вересковых М. Райнер, 'растения почв, бедных нитратами (азотом), разрешили проблему жизни на этих почвах ценой своей независимости'
Ферменты грибов в случае микоризы вересковых играют, по-видимому, большую роль в разложении сложных азото-содержащих соединений, не доступных иначе растениям. Многие авторы указывают на то, что между растениями, живущими на почвах, бедных легкоусвояемыми соединениями азота, происходит особенно ожесточенная борьба за источники азота. В ходе этой борьбы выработались такие замечательные приспособления, как насе-комоядность, например у росянки — жительницы болот, или сожительство с азот-фиксирующими бактериями у некоторых других растений. Очевидно, нечто подобное можно сказать и о сожительстве растений с грибами.
По данным многих авторов, грибы, сожительствующие с вересковыми, могут уменьшать вредное воздействие на эти растения торфяных почв. К грибам, образующим микоризу вересковых, относятся виды рода питиум из оомицетов, мортие-реллы из зигомицетов, пецицеллы из сумчатых, клаварии из базидиомицетов, фома из дейтеромицетов, т. е. представители почти всех классов грибов.
Некоторые растения имеют микоризу как бы промежуточного типа между экто-трофной и эндотрофной. Например, виды семейства грушанковых, у которых корневые окончания не имеют корневых волосков, окружены грибным чехлом, имеют сеть Гартига и содержат клубки гиф в клетках эпидермиса. Одна из грушанок Северной Америки, не имеющая листьев, паразитирует на своем грибе.
Ископаемые остатки показывают, что древнейшие высшие растения каменноугольного и девонского периодов палеозойской эры уже имели микоризу. Формирование ее происходило, по-видимому, так, что первоначально гриб начинал паразитировать на растении, стремясь уйти от конкуренции с почвенными сапротрофными микроорганизмами, но высшее растение защищалось, и впоследствии установились более или менее сбалансированные отношения. В одних случаях закрепился односторонний хронический, не сильно вредящий паразитизм гриба на высшем растении (многие арбускулярно-везикулярные эндотрофные микоризы), в других — аллело-паразитизм (микоризы древесных пород, зеленых орхидей), в третьих — паразитизм высшего растения на грибе (бесхлорофил-льные орхидеи, заростки плауновых и др.).
В последние годы возникло еще одно очень важное и перспективное направление в изучении как почвенных микроскопических грибов, так и вопросов, связанных с микоризообразованием. Дело в том, что в связи с высокими и непрерывно растущими темпами развития промышленности и добычи полезных ископаемых большие территории земной поверхности оказываются нарушенными. Например, в тех местах, где ведется подземная добыча полезных ископаемых, породы, покрывающие поверхность земли, проседают, образуя углубления рельефа, на месте которых иногда развиваются болота. Кроме того, на таких просадках обычно образуются разрывы корней деревьев и деревья погибают. Отвалы после разработок также уменьшают полезную поверхность земли, часто содержат токсические вещества, загрязняют воздух.
Возвращение нарушенных земель в хозяйственное использование имеет первостепенное значение. На отвалах, старых выработках, шахтах, местах добычи торфа и тому подобных неудобных землях часто выращивают леса и парки. Такая практика сложилась уже в большинстве стран. Для каждого региона при этом требуется разработка соответствующей системы мероприятий со строгим учетом всех факторов среды и подбор определенных пород деревьев и кустарников.
Если учесть все то, что было сказано о роли грибов в процессах почвообразования, становится ясным их значение, например, в деле превращения горных пород в первичную почву, т. е. в разрушении минералов и образовании соединений, способных усваиваться растениями, в оструктури-вании почвы, трансформации органических остатков, формировании гумуса, разрушении токсических веществ и т. д.
Велико значение грибов и как микоризо-образователей, так как развитие микоризы может обеспечить и хорошее развитие соответствующих пород. В отвалах практически отсутствуют доступные для растений азотные соединения, но такая, например, порода, как береза, или хвойные могут обеспечить себя этими соединениями, образуя микоризу. В ряде случаев, особенно в посадках сосны на отвалах, наблюдалось обильное развитие микоризы, которое сопровождалось улучшением роста деревьев. Вскоре в таких посадках появлялись и плодовые тела грибов.
Грибы — враги и санитары леса
Роль грибов в болезнях леса
 Без этих скромных санитаров лес был бы завален грудами мертвых стволов
Микроскопические и макроскопические грибы вызывают различные болезни деревьев, кустарников, дикорастущих трав, возделываемых культур, вследствие чего у растений происходит нарушение нормального обмена веществ, приводящее к снижению их продуктивности, а иногда и к гибели.
Грибные заболевания наносят огромный урон лесу. Так, от голландской болезни вязов, или графиоза, в США только в 1976-1977 гг. погибло 38 тыс. деревьев, чем был причинен ущерб на 30 млн. долларов (они были истрачены только на то, чтобы убрать и уничтожить погибшие деревья). У нас в стране подсчитано, что инфекционное усыхание дубов в возрасте 80 лет наносит экономический вред, исчисляемый в сумме 415 р. 50 к. при пересчете на 1 га(Минкевич И. И. Эпифитотиология грибных болезней лесных пород (трахеомикоз некроз коры, рак). Л., 1977, с. 63). Гибель деревьев и кустарников ведет к резкой перестройке всего растительного сообщества, изменению защитных свойств леса:
• нарушаются обогащение атмосферы кислородом,
• водорегулирующая,
• водоохранная и почвозащитная функции леса,
• снижается урожай ягод и грибов,
• лекарственных растений и т. д.
Среди возбудителей болезней леса имеются грибы, приуроченные к одной породе дерева или кустарника или к нескольким породам. Некоторые возбудители поражают всходы, другие — молодые деревца, взрослые деревья, свежесрубленную древесину или древесину на складах и в сооружениях и т. д.
В зависимости от пищевых потребностей возбудителей болезней леса различают облигатных (обязательных) сапротрофов. Это макро- и микромицеты, не способные развиваться в (на) живых тканях и обитающие только на отмершей древесине. К ним относятся складские и домовые грибы, разрушающие древесину на складах и в постройках, микромицеты, вызывающие поверхностное плесневение плодов, семян, синеву древесины (возбудители синевы древесины обычно развиваются на свежесрубленной древесине, придавая ей синеватый оттенок). Грибы, обычно живущие сапротрофно, но заражающие и живые растения, чаще ослабленные неблагоприятными воздействиями окружающей среды, называются факультативными паразитами или полусапротрофами. Таковыми являются возбудители заболевания, вызывающего полегание сеянцев древесных растений. В противоположность полусапротрофам факультативные сапротрофы ведут обычно паразитический образ жизни. Их цикл развития двухфазный: во время вегетационного периода они паразитируют на живых деревьях и кустарниках, а завершают цикл сапротрофно на опавших листьях, хвое, засохших ветвях и т. д. Грибы этой группы представлены главным образом сумчатыми и несовершенными, реже базидиомицетами. Например, серно-желтый трутовик, березовая губка начинают свое развитие на живых деревьях, а продолжают его после их гибели. Некротрофы питаются мертвыми растительными тканями, но предварительно убитыми токсическими выделениями самого возбудителя болезни. К таким грибам относятся виды рода фузариум, вызывающие увядание сеянцев многих древесных и других растений, а также опенок — виновник усыхания древесных, в том числе плодовых, культур. Все эти грибы способны развиваться на искусственных питательных средах.
Облигатные паразиты, или биотрофы, — грибы, постоянно обитающие на (в) живых тканях дерева и утратившие способность к сапротрофному питанию, к ним относятся мучнисторосяные, тафриновые и ржавчинные. Эти грибы практически не могут развиваться на искусственных питательных средах, хотя в последнее время появились сведения о возможности культивирования, например, ржавчинных грибов.
Перечисленные выше группы возбудителей болезней леса представляют организмы с постепенно сложившимися на протяжении длительного времени определенными взаимоотношениями с субстратом.
Без сомнения, грибы были полноправными членами лесов древних эпох. До нас дошли ископаемые отпечатки листьев со следами пятнистостей, обнаружены остатки паразитных грибов в различных органах лепидодендронов, или чешуедревов, и других вымерших ныне растений.
Пятнистость, или некроз, — отдельные участки отмершей ткани листьев, иногда плодов, побегов, коры стволов и ветвей — один из наиболее распространенных симптомов заболеваний лесных пород. Растение заболевает в результате распространения внутри его тканей мицелия, который разрушает и убивает клетки. На пятнах различной формы и цвета развиваются спороношения микромицетов. Известны и другие симптомы, например парша, которая проявляется в виде растрескивающихся струпьевидных и шелушащихся участков пораженных покровных тканей и распространена у яблонь и груш, осины и тополя. Возбудители парши — гифомицеты и сумчатые грибы. Еще одно заболевание — шютте проявляется в изменении окраски, отмирании и опадении хвои, на которой развиваются спороношения микромицетов.
Без этих скромных санитаров лес был бы завален грудами мертвых стволов
Микроскопические и макроскопические грибы вызывают различные болезни деревьев, кустарников, дикорастущих трав, возделываемых культур, вследствие чего у растений происходит нарушение нормального обмена веществ, приводящее к снижению их продуктивности, а иногда и к гибели.
Грибные заболевания наносят огромный урон лесу. Так, от голландской болезни вязов, или графиоза, в США только в 1976-1977 гг. погибло 38 тыс. деревьев, чем был причинен ущерб на 30 млн. долларов (они были истрачены только на то, чтобы убрать и уничтожить погибшие деревья). У нас в стране подсчитано, что инфекционное усыхание дубов в возрасте 80 лет наносит экономический вред, исчисляемый в сумме 415 р. 50 к. при пересчете на 1 га(Минкевич И. И. Эпифитотиология грибных болезней лесных пород (трахеомикоз некроз коры, рак). Л., 1977, с. 63). Гибель деревьев и кустарников ведет к резкой перестройке всего растительного сообщества, изменению защитных свойств леса:
• нарушаются обогащение атмосферы кислородом,
• водорегулирующая,
• водоохранная и почвозащитная функции леса,
• снижается урожай ягод и грибов,
• лекарственных растений и т. д.
Среди возбудителей болезней леса имеются грибы, приуроченные к одной породе дерева или кустарника или к нескольким породам. Некоторые возбудители поражают всходы, другие — молодые деревца, взрослые деревья, свежесрубленную древесину или древесину на складах и в сооружениях и т. д.
В зависимости от пищевых потребностей возбудителей болезней леса различают облигатных (обязательных) сапротрофов. Это макро- и микромицеты, не способные развиваться в (на) живых тканях и обитающие только на отмершей древесине. К ним относятся складские и домовые грибы, разрушающие древесину на складах и в постройках, микромицеты, вызывающие поверхностное плесневение плодов, семян, синеву древесины (возбудители синевы древесины обычно развиваются на свежесрубленной древесине, придавая ей синеватый оттенок). Грибы, обычно живущие сапротрофно, но заражающие и живые растения, чаще ослабленные неблагоприятными воздействиями окружающей среды, называются факультативными паразитами или полусапротрофами. Таковыми являются возбудители заболевания, вызывающего полегание сеянцев древесных растений. В противоположность полусапротрофам факультативные сапротрофы ведут обычно паразитический образ жизни. Их цикл развития двухфазный: во время вегетационного периода они паразитируют на живых деревьях и кустарниках, а завершают цикл сапротрофно на опавших листьях, хвое, засохших ветвях и т. д. Грибы этой группы представлены главным образом сумчатыми и несовершенными, реже базидиомицетами. Например, серно-желтый трутовик, березовая губка начинают свое развитие на живых деревьях, а продолжают его после их гибели. Некротрофы питаются мертвыми растительными тканями, но предварительно убитыми токсическими выделениями самого возбудителя болезни. К таким грибам относятся виды рода фузариум, вызывающие увядание сеянцев многих древесных и других растений, а также опенок — виновник усыхания древесных, в том числе плодовых, культур. Все эти грибы способны развиваться на искусственных питательных средах.
Облигатные паразиты, или биотрофы, — грибы, постоянно обитающие на (в) живых тканях дерева и утратившие способность к сапротрофному питанию, к ним относятся мучнисторосяные, тафриновые и ржавчинные. Эти грибы практически не могут развиваться на искусственных питательных средах, хотя в последнее время появились сведения о возможности культивирования, например, ржавчинных грибов.
Перечисленные выше группы возбудителей болезней леса представляют организмы с постепенно сложившимися на протяжении длительного времени определенными взаимоотношениями с субстратом.
Без сомнения, грибы были полноправными членами лесов древних эпох. До нас дошли ископаемые отпечатки листьев со следами пятнистостей, обнаружены остатки паразитных грибов в различных органах лепидодендронов, или чешуедревов, и других вымерших ныне растений.
Пятнистость, или некроз, — отдельные участки отмершей ткани листьев, иногда плодов, побегов, коры стволов и ветвей — один из наиболее распространенных симптомов заболеваний лесных пород. Растение заболевает в результате распространения внутри его тканей мицелия, который разрушает и убивает клетки. На пятнах различной формы и цвета развиваются спороношения микромицетов. Известны и другие симптомы, например парша, которая проявляется в виде растрескивающихся струпьевидных и шелушащихся участков пораженных покровных тканей и распространена у яблонь и груш, осины и тополя. Возбудители парши — гифомицеты и сумчатые грибы. Еще одно заболевание — шютте проявляется в изменении окраски, отмирании и опадении хвои, на которой развиваются спороношения микромицетов.
 Пятнистости листьев, вызываемые грибами, уменьшают зеленую фотосинтезирующую поверхность листа, и растение страдает от недостатка питательных веществ
Ржавчина, вызываемая ржавчинными грибами, поражает и травы, и деревья, и кустарники. Ржавчинные грибы вызывают на листьях, хвое, коре стволов и ветвей оранжево-желтые, буро-коричневые или почти черные спороношения (пустулы), выступающие наружу через разрывы тканей. Ржавчинные грибы многолики. Им свойственно чередование в жизненном цикле нескольких спороношений, или плеоморфизм. У них есть три весенних спороношения, одно летнее и одно осеннее, зимующее, которое весной прорастает в определенное весеннее. Они настолько несхожи, что трудно представить, что это дети одного и того же родителя. Среди ржавчинных грибов есть виды, развивающиеся на разных растениях-хозяевах, и такие, у которых один хозяин. Некоторые ржавчинные грибы имеют полный цикл развития (на одном или двух растениях-хозяевах чередуются все спороношения), а другие — неполный, у них в жизненном цикле одно из спороношений не развивается. Иногда ржавчинные грибы вызывают различного рода деформации пораженных органов — заболевание сосновый вертун. Оно поражает древесину сосны в результате воздействия на нее гриба мелампсора. У пораженных деревьев нарушается нормальное развитие отдельных ветвей.
Пятнистости листьев, вызываемые грибами, уменьшают зеленую фотосинтезирующую поверхность листа, и растение страдает от недостатка питательных веществ
Ржавчина, вызываемая ржавчинными грибами, поражает и травы, и деревья, и кустарники. Ржавчинные грибы вызывают на листьях, хвое, коре стволов и ветвей оранжево-желтые, буро-коричневые или почти черные спороношения (пустулы), выступающие наружу через разрывы тканей. Ржавчинные грибы многолики. Им свойственно чередование в жизненном цикле нескольких спороношений, или плеоморфизм. У них есть три весенних спороношения, одно летнее и одно осеннее, зимующее, которое весной прорастает в определенное весеннее. Они настолько несхожи, что трудно представить, что это дети одного и того же родителя. Среди ржавчинных грибов есть виды, развивающиеся на разных растениях-хозяевах, и такие, у которых один хозяин. Некоторые ржавчинные грибы имеют полный цикл развития (на одном или двух растениях-хозяевах чередуются все спороношения), а другие — неполный, у них в жизненном цикле одно из спороношений не развивается. Иногда ржавчинные грибы вызывают различного рода деформации пораженных органов — заболевание сосновый вертун. Оно поражает древесину сосны в результате воздействия на нее гриба мелампсора. У пораженных деревьев нарушается нормальное развитие отдельных ветвей.
 Ржавчинные грибы на листьях рябины
Ржавчинные грибы вызывают и рак — заболевание, проявляющееся в образовании наростов (опухолей) вследствие разрастания пораженных тканей дерева, незарастающих, окруженных наплывом ран и сопровождающееся смолотечением больных стволов, ветвей и корней. Специфический признак поражения ржавчинными грибами — пустулы, а деформация и рак пораженных органов — это чаще симптомы заражения деревьев разными микромицетами.
Ржавчинные грибы на листьях рябины
Ржавчинные грибы вызывают и рак — заболевание, проявляющееся в образовании наростов (опухолей) вследствие разрастания пораженных тканей дерева, незарастающих, окруженных наплывом ран и сопровождающееся смолотечением больных стволов, ветвей и корней. Специфический признак поражения ржавчинными грибами — пустулы, а деформация и рак пораженных органов — это чаще симптомы заражения деревьев разными микромицетами.
 Ржавчинные грибы на листьях черной смородины
Микромицеты могут также мумифицировать плоды или семена, т. е. превращать их в плотные черные образования — склероциальные стромы, или склероции, образно говоря, в мумию. При мумификации мицелий разрастается в ткани пораженного органа, иногда изменяя его форму (в редких случаях — не изменяя), и препятствует его функции. Мумифицированные плоды и семена не прорастают.
Все перечисленные симптомы вызываются грибами, мицелий которых развивается внутри пораженного органа, но есть заболевания, мицелий возбудителей которых распространяется на поверхности пораженного органа. Бросающиеся в глаза тонкие паутинистые налеты, иногда плотные, порошащие, напоминающие муку, образуют мучнисторосяные грибы, такие же налеты, но окрашенные — различные плесневые грибы, вызывающие болезни плодов и семян. Черные сажистые налеты (чернь) свойственны видам грибов рода капнодиум. Эти грибы-эпифиты развиваются поверхностно на листьях. Обычно они приурочены к тем листьям, на которых обитают тли, выделяющие сахаристую жидкость. Этим "лакомством" и питаются грибы. Мицелий грибов, покрывающий поверхность листа, снижает фотосинтез, что сказывается на развитии листовой пластинки и всего растения. Чернь часто заметна на листьях ив.
Гибель целого дерева или отдельных крупных ветвей вызывают чаще возбудители сосудистых заболеваний и гнилей. Сосудистые болезни (трахеомикозы) сопровождаются увяданием дерева вследствие нарушения функционирования проводящей системы, а вызывают их несколько видов микромицетов.
Гнили развиваются в результате деятельности микро- и макромицетов и характеризуются резким нарушением структуры древесины, разрушением ее под действием ферментативных систем грибов. Тип гнили определяется составом ферментов возбудителей. В зависимости от того, какими ферментами обладают ксилотрофы, т. е. дереворазрушающие грибы, и в какой последовательности они воздействуют на компоненты оболочек клеток, различают две группы грибов — возбудителей гнилей: целлюлозоразрушающие и лигнинразрушающие. Они содержат гидролитические ферменты, разлагающие сложные органические вещества на более простые, а лигнинразрушающие грибы имеют еще и оксидазы, т. е. окислительные ферменты.
Грибы первой группы вызывают деструктивную гниль — разрушают целлюлозу (клетчатку), одну из основных частей оболочек растительных клеток, что способствует освобождению лигнина (это сложное органическое вещество, в древесине его содержится около 30%). В результате деструкции целлюлозы древесина становится хрупкой, ломкой, крошащейся и в конце концов растрескивается на крупные или мелкие призматические куски, легко растирающиеся в порошок. Постепенно изменяется и цвет ее — от красноватого до темно-бурого, отсюда и другое название гнили — бурая.
Ржавчинные грибы на листьях черной смородины
Микромицеты могут также мумифицировать плоды или семена, т. е. превращать их в плотные черные образования — склероциальные стромы, или склероции, образно говоря, в мумию. При мумификации мицелий разрастается в ткани пораженного органа, иногда изменяя его форму (в редких случаях — не изменяя), и препятствует его функции. Мумифицированные плоды и семена не прорастают.
Все перечисленные симптомы вызываются грибами, мицелий которых развивается внутри пораженного органа, но есть заболевания, мицелий возбудителей которых распространяется на поверхности пораженного органа. Бросающиеся в глаза тонкие паутинистые налеты, иногда плотные, порошащие, напоминающие муку, образуют мучнисторосяные грибы, такие же налеты, но окрашенные — различные плесневые грибы, вызывающие болезни плодов и семян. Черные сажистые налеты (чернь) свойственны видам грибов рода капнодиум. Эти грибы-эпифиты развиваются поверхностно на листьях. Обычно они приурочены к тем листьям, на которых обитают тли, выделяющие сахаристую жидкость. Этим "лакомством" и питаются грибы. Мицелий грибов, покрывающий поверхность листа, снижает фотосинтез, что сказывается на развитии листовой пластинки и всего растения. Чернь часто заметна на листьях ив.
Гибель целого дерева или отдельных крупных ветвей вызывают чаще возбудители сосудистых заболеваний и гнилей. Сосудистые болезни (трахеомикозы) сопровождаются увяданием дерева вследствие нарушения функционирования проводящей системы, а вызывают их несколько видов микромицетов.
Гнили развиваются в результате деятельности микро- и макромицетов и характеризуются резким нарушением структуры древесины, разрушением ее под действием ферментативных систем грибов. Тип гнили определяется составом ферментов возбудителей. В зависимости от того, какими ферментами обладают ксилотрофы, т. е. дереворазрушающие грибы, и в какой последовательности они воздействуют на компоненты оболочек клеток, различают две группы грибов — возбудителей гнилей: целлюлозоразрушающие и лигнинразрушающие. Они содержат гидролитические ферменты, разлагающие сложные органические вещества на более простые, а лигнинразрушающие грибы имеют еще и оксидазы, т. е. окислительные ферменты.
Грибы первой группы вызывают деструктивную гниль — разрушают целлюлозу (клетчатку), одну из основных частей оболочек растительных клеток, что способствует освобождению лигнина (это сложное органическое вещество, в древесине его содержится около 30%). В результате деструкции целлюлозы древесина становится хрупкой, ломкой, крошащейся и в конце концов растрескивается на крупные или мелкие призматические куски, легко растирающиеся в порошок. Постепенно изменяется и цвет ее — от красноватого до темно-бурого, отсюда и другое название гнили — бурая.
 Под действием ферментов дрероразрушающих грибов нарушается структура древесины, изменяется ее цвет
Грибы второй группы вызывают коррозионную гниль — разлагают лигнин. При быстрой деструкции древесины этими грибами в пораженной древесине появляются пустоты вследствие гниения групп клеток — они хорошо видны невооруженным глазом и заполнены неразложившейся целлюлозой. По окраске такая гниль пестрая (стандартное название этого типа гнили в случае, если она вызвана сосновой губкой, — ситовина или ситовая древесина). В отличие от пестрой гнили при белой гнили происходит постепенное разрушение лигнина оболочек клеток. В результате этого процесса в пустотах также накапливается неразложившаяся целлюлоза в виде так называемых выцветов, а оболочка клеток набухает и расслаивается. Древесина становится мягкой, волокнистой, расщепляется по годичным кольцам и белеет. Некоторые древоразрушающие грибы способны вызывать смешанную гниль, воздействуя на целлюлозный и лигниновый комплексы древесины.
Под действием ферментов дрероразрушающих грибов нарушается структура древесины, изменяется ее цвет
Грибы второй группы вызывают коррозионную гниль — разлагают лигнин. При быстрой деструкции древесины этими грибами в пораженной древесине появляются пустоты вследствие гниения групп клеток — они хорошо видны невооруженным глазом и заполнены неразложившейся целлюлозой. По окраске такая гниль пестрая (стандартное название этого типа гнили в случае, если она вызвана сосновой губкой, — ситовина или ситовая древесина). В отличие от пестрой гнили при белой гнили происходит постепенное разрушение лигнина оболочек клеток. В результате этого процесса в пустотах также накапливается неразложившаяся целлюлоза в виде так называемых выцветов, а оболочка клеток набухает и расслаивается. Древесина становится мягкой, волокнистой, расщепляется по годичным кольцам и белеет. Некоторые древоразрушающие грибы способны вызывать смешанную гниль, воздействуя на целлюлозный и лигниновый комплексы древесины.
 Гнили хвойных пород: 1, 2 — стволовые гнили; 3, 4 — гниль ствола и ветвей; 5 — корневая и комлевая гниль; 6 — корневая гниль
Гниение древесины — процесс динамический и протекает в несколько стадий. Каждая стадия — показатель степени разрушения древесины и характеризуется изменением ее окраски и структуры. Различают четыре стадии :
• начальную,
• промежуточную,
• конечную
• стадию дупла;
на последней начинается механический распад древесины. От момента заражения дерева базидиоспорами макромицетов — возбудителей гнилевых болезней — и начала гниения до наступления конечной стадии проходит разное время. Продолжительность течения каждой стадии характеризуется скоростью гниения — медленной, быстрой и очень быстрой. Она зависит от биологических особенностей возбудителя гнили, состояния живого дерева, физических свойств древесины и условий внешней среды. Например, скорость распространения гнили, вызываемой корневой губкой, 48 см в год.
У древесных пород, пораженных гнилями, наблюдается резкое нарушение физиолого-биохимических процессов, ослабляющее деревья и снижающее прирост древесины. В зависимости от биологических особенностей возбудителей гнили располагаются в дереве различно и по-разному влияют на его жизненные процессы и технические свойства древесины. Биологически наиболее вредоносны корневые и заболонные гнили стволов. Первые способствуют нарушению функций корневой системы и ветровалу деревьев, а вторые изменяют нормальное распределение в дереве питательных веществ. Гнили корней и стволов наблюдаются главным образом в насаждениях, подвергающихся неблагоприятным климатическим, биотическим и антропогенным воздействиям; их вызывают плохой уход за лесом, непланомерный выпас скота, засуха, неправильное проведение мелиоративных работ и т. д.
Грибные болезни могут принести огромный ущерб лесному хозяйству, если становятся массовыми, т. е. превращаются в эпифитотии. Такого размаха они могут достичь и на небольшой территории и на огромных площадях в разных странах или на разных континентах.
В истории лесной фитопатологии известны примеры прогрессирующих эпифитотии, развитие которых обычно начиналось в определенной местности и затем охватывало огромные территории. Например, в 1904 г. возбудитель рака каштана был случайно завезен в США из Китая. Американский каштан оказался восприимчив к новому паразиту, и уже к 1908 г. в ряде штатов от заболевания погибло от 50 до 90% деревьев, а к 1952 г. все крупные деревья были уничтожены. Особенно пострадали от этого заболевания каштаны в районе Аппалачских гор.
Еще более трагично шествие по странам и континентам голландской болезни, или графиоза, ильмовых пород. Впервые она была обнаружена в 1918 г. во Франции. Ее возбудитель — графиум вяза, давший второе название болезни. Это конидиальная стадия сумчатого гриба — цератоцис-тиса вяза. С чрезвычайной быстротой эта болезнь распространилась по Европейскому континенту, вызвав опустошительные эпифитотии, а в 1930 г. заболевание перекинулось и на Американский континент. В течение нескольких лет на территории США погибло 3 млн. деревьев.
В СССР графиоз впервые был отмечен в 1936 г. Эпифитотии этой болезни были зарегистрированы в периоды 1936- 1941 гг. и 1955-1959 гг. Заболевание вызвало усыхание вязов в лесах, полезащитных лесных полосах, городских насаждениях. Быстрое распространение его связано с несколькими причинами. Во-первых, среди ильмовых практически нет устойчивых к этому заболеванию пород. Высокой устойчивостью к графиозу характеризуется лишь вяз перистоветвистый, гибридизацией которого с целью получения более устойчивых форм к возбудителю и к абиотическим факторам среды занимаются ученые-лесоводы. Во-вторых, в цикле развития возбудителя известны несколько биологических типов спороношений. Наиболее опасен графиум, образующий коремии — темные, плотно склеенные друг с другом пучки конидиеносцев, на вершине которых в виде головки скапливается множество спор, погруженных в слизь.
Они развиваются весной под корой и в ходах жуков-заболонников и других стволовых вредителей. Конидии распространяются насекомыми, брызгами дождя и ветром. В-третьих, первичная инфекция проникает в свежие поранения коры дерева при питании молодых жуков после их вылета из зараженных деревьев. Обычно это наблюдается в мае-июне, что совпадает со временем образования спороношения возбудителя заболевания, которому благоприятствует теплая и влажная погода. Разносится инфекция и летом — при вылете жуков второй генерации. В-четвертых, жуки-заболонники разносят инфекцию с пораженных деревьев в радиусе их разлета, т. е. до 400 м, а каждое новое заболевшее дерево становится источником болезни. Инфицировать здоровые деревья могут и споры возбудителя, находящиеся в воздухе над заболевшими деревьями, переносимые воздушными течениями и оседающие на восприимчивые растения. Инфекция передается мицелием и конидиями от зараженных материнских деревьев, пневой и корневой поросли. Источником инфекции служат не только усохшие и усыхающие деревья, но и порубочные остатки зараженных деревьев: кора, щепа, древесина, ветви и т. д. Заболевание протекает в острой и хронической формах, при острой гибель наступает в течение нескольких недель, при хронической — через несколько лет.
Гнили хвойных пород: 1, 2 — стволовые гнили; 3, 4 — гниль ствола и ветвей; 5 — корневая и комлевая гниль; 6 — корневая гниль
Гниение древесины — процесс динамический и протекает в несколько стадий. Каждая стадия — показатель степени разрушения древесины и характеризуется изменением ее окраски и структуры. Различают четыре стадии :
• начальную,
• промежуточную,
• конечную
• стадию дупла;
на последней начинается механический распад древесины. От момента заражения дерева базидиоспорами макромицетов — возбудителей гнилевых болезней — и начала гниения до наступления конечной стадии проходит разное время. Продолжительность течения каждой стадии характеризуется скоростью гниения — медленной, быстрой и очень быстрой. Она зависит от биологических особенностей возбудителя гнили, состояния живого дерева, физических свойств древесины и условий внешней среды. Например, скорость распространения гнили, вызываемой корневой губкой, 48 см в год.
У древесных пород, пораженных гнилями, наблюдается резкое нарушение физиолого-биохимических процессов, ослабляющее деревья и снижающее прирост древесины. В зависимости от биологических особенностей возбудителей гнили располагаются в дереве различно и по-разному влияют на его жизненные процессы и технические свойства древесины. Биологически наиболее вредоносны корневые и заболонные гнили стволов. Первые способствуют нарушению функций корневой системы и ветровалу деревьев, а вторые изменяют нормальное распределение в дереве питательных веществ. Гнили корней и стволов наблюдаются главным образом в насаждениях, подвергающихся неблагоприятным климатическим, биотическим и антропогенным воздействиям; их вызывают плохой уход за лесом, непланомерный выпас скота, засуха, неправильное проведение мелиоративных работ и т. д.
Грибные болезни могут принести огромный ущерб лесному хозяйству, если становятся массовыми, т. е. превращаются в эпифитотии. Такого размаха они могут достичь и на небольшой территории и на огромных площадях в разных странах или на разных континентах.
В истории лесной фитопатологии известны примеры прогрессирующих эпифитотии, развитие которых обычно начиналось в определенной местности и затем охватывало огромные территории. Например, в 1904 г. возбудитель рака каштана был случайно завезен в США из Китая. Американский каштан оказался восприимчив к новому паразиту, и уже к 1908 г. в ряде штатов от заболевания погибло от 50 до 90% деревьев, а к 1952 г. все крупные деревья были уничтожены. Особенно пострадали от этого заболевания каштаны в районе Аппалачских гор.
Еще более трагично шествие по странам и континентам голландской болезни, или графиоза, ильмовых пород. Впервые она была обнаружена в 1918 г. во Франции. Ее возбудитель — графиум вяза, давший второе название болезни. Это конидиальная стадия сумчатого гриба — цератоцис-тиса вяза. С чрезвычайной быстротой эта болезнь распространилась по Европейскому континенту, вызвав опустошительные эпифитотии, а в 1930 г. заболевание перекинулось и на Американский континент. В течение нескольких лет на территории США погибло 3 млн. деревьев.
В СССР графиоз впервые был отмечен в 1936 г. Эпифитотии этой болезни были зарегистрированы в периоды 1936- 1941 гг. и 1955-1959 гг. Заболевание вызвало усыхание вязов в лесах, полезащитных лесных полосах, городских насаждениях. Быстрое распространение его связано с несколькими причинами. Во-первых, среди ильмовых практически нет устойчивых к этому заболеванию пород. Высокой устойчивостью к графиозу характеризуется лишь вяз перистоветвистый, гибридизацией которого с целью получения более устойчивых форм к возбудителю и к абиотическим факторам среды занимаются ученые-лесоводы. Во-вторых, в цикле развития возбудителя известны несколько биологических типов спороношений. Наиболее опасен графиум, образующий коремии — темные, плотно склеенные друг с другом пучки конидиеносцев, на вершине которых в виде головки скапливается множество спор, погруженных в слизь.
Они развиваются весной под корой и в ходах жуков-заболонников и других стволовых вредителей. Конидии распространяются насекомыми, брызгами дождя и ветром. В-третьих, первичная инфекция проникает в свежие поранения коры дерева при питании молодых жуков после их вылета из зараженных деревьев. Обычно это наблюдается в мае-июне, что совпадает со временем образования спороношения возбудителя заболевания, которому благоприятствует теплая и влажная погода. Разносится инфекция и летом — при вылете жуков второй генерации. В-четвертых, жуки-заболонники разносят инфекцию с пораженных деревьев в радиусе их разлета, т. е. до 400 м, а каждое новое заболевшее дерево становится источником болезни. Инфицировать здоровые деревья могут и споры возбудителя, находящиеся в воздухе над заболевшими деревьями, переносимые воздушными течениями и оседающие на восприимчивые растения. Инфекция передается мицелием и конидиями от зараженных материнских деревьев, пневой и корневой поросли. Источником инфекции служат не только усохшие и усыхающие деревья, но и порубочные остатки зараженных деревьев: кора, щепа, древесина, ветви и т. д. Заболевание протекает в острой и хронической формах, при острой гибель наступает в течение нескольких недель, при хронической — через несколько лет.
 Усыхание верхушечных ветвей — один из первых признаков графиоза вяза
Примерами эпифитотии, охватывающих огромные площади отдельных стран или континентов, может быть также массовое распространение мучнистой росы дуба в начале XX в., распространение корневой губки в хвойных лесах многих стран Европы и Северной Америки; Знание закономерностей развития эпифитотий разных типов позволяет прогнозировать их. Советский ученый И. И. Минкевич и голландский ученый Я. ван дер Планк много сделали для составления математически обоснованных прогнозов развития эпифитотий вообще и заболеваний лесных пород в частности.
Усыхание верхушечных ветвей — один из первых признаков графиоза вяза
Примерами эпифитотии, охватывающих огромные площади отдельных стран или континентов, может быть также массовое распространение мучнистой росы дуба в начале XX в., распространение корневой губки в хвойных лесах многих стран Европы и Северной Америки; Знание закономерностей развития эпифитотий разных типов позволяет прогнозировать их. Советский ученый И. И. Минкевич и голландский ученый Я. ван дер Планк много сделали для составления математически обоснованных прогнозов развития эпифитотий вообще и заболеваний лесных пород в частности.
Микромицеты — возбудители болезней древесных пород
Для получения 2 млн. саженцев с 1 га питомника необходимо 60 кг здоровых семян. Но, оказывается, семена и плоды могут заболеть еще на дереве или кустарнике во время вегетации. Внешние признаки болезней разнообразны. Наиболеечасто встречаются деформация и мумификация плодов и семян, ржавчина, пятнистости. Возбудители деформации плодов относятся к сумчатым грибам из рода тафрина, которые наиболее часто поражают косточковые породы (черемуху, алычу, сливу и т. д.). Механизм воздействия гриба на плоды косточковых пород следующий: мицелий, распространяясь по тканям завязи, вызывает ее разрастание и одновременно приводит к подавлению развития косточки. В результате образуются мешковидные, уродливые тела "кармашки" или "дутые плоды". Вся поверхность таких плодов состоит из тесно расположенных сумок возбудителя, созревающих во вторую половину лета и тогда же выбрасывающих споры, заражающие чешуйки почек. Деформация плодов ольхи и тополя также вызывается грибами, зимующими в почках, откуда весной после цветения проникает в женские сережки. У ольхи заболевание проявляется в деформации семян и разрастании чешуек в уродливые образования. Семенная продуктивность пораженных деревьев значительно снижается. Мумификация плодов и семян также вызывается сумчатыми грибами, но из рода склеротиния. Мумификация — это заключительный этап развития заболевания, при котором пораженные органы превращаются в склероции, которые обычно состоят из мицелия пронизывающего ткани пораженного органа, и из сильно измененных тканей растения-хозяина. Склероции, образующиеся на семенах березы и ольхи, очень мелкие, а склероции возбудителя мумификации желудей, например, крупные. Черный цвет оболочек клеток поверхностных слоев склероциев обусловлен пигментами группы меланинов. Эта окраска предохраняет их от губительного воздействия ультрафиолетовых лучей и других неблагоприятных факторов внешней среды. В цикле развития этих грибов склероции играют роль покоящихся стадий, в которых гриб зимует. Весной из склероциев вырастают плодовые тела этих грибов, несущие сумкоспоры. Мумификация семян березы и ольхи происходит при заражении цветов сумкоспорами, а желудей — мицелием при контакте больных и здоровых плодов. Известна мумификация плодов также у каштана, рябины и боярышника. Семена березы, зараженные грибом склеротинией
Другое заболевание плодов и семян, развивающееся во время вегетационного периода, — ржавчина шишек ели. Пораженные шишки имеют широко раскрытые чешуи, более темный цвет, а на внутренней их поверхности заметны многочисленные темно-коричневые шаровидные споровместилища этого гриба, называемого текопсора черемухи. Возбудитель ржавчины шишек имеет полный цикл развития со сменой хозяев — черемухи и ели. Весенние споры развиваются соответственно на внешней и внутренней поверхности кроющих чешуй шишек ели. Созрев, они ветром переносятся на листья разных видов черемухи, где развиваются летние и осенние споры. Пораженные листья черемухи покрываются сначала беловатыми, впоследствии фиолетового или буровато-малинового цвета угловатыми пятнами. Такие листья преждевременно опадают, а весной осенние перезимовавшие на опавших листьях споры прорастают в новое спороношение, которое заражает шишки ели. Подобный цикл развития имеет и другой возбудитель ржавчины шишек — хризомикса грушанки. Оба возбудителя легко различимы. Последний на кроющих чешуйках шишек образует два крупных оранжевого цвета весенних споровместилища. Промежуточный хозяин этого гриба — грушанки. Грушанки интересны тем, что листья у них круглый год зеленые. В таких листьях и зимует мицелий гриба с осенними спорами. Летом можно найти экземпляры грушанок, прошлогодние листья которых засохли в результате поражения грибом, а на новых листочках заметны яркие оранжевые пустулы гриба — результат заражения текущего года. Зараженные грушанки не образуют стройных цветоносов с белоснежными цветами.
Семена березы, зараженные грибом склеротинией
Другое заболевание плодов и семян, развивающееся во время вегетационного периода, — ржавчина шишек ели. Пораженные шишки имеют широко раскрытые чешуи, более темный цвет, а на внутренней их поверхности заметны многочисленные темно-коричневые шаровидные споровместилища этого гриба, называемого текопсора черемухи. Возбудитель ржавчины шишек имеет полный цикл развития со сменой хозяев — черемухи и ели. Весенние споры развиваются соответственно на внешней и внутренней поверхности кроющих чешуй шишек ели. Созрев, они ветром переносятся на листья разных видов черемухи, где развиваются летние и осенние споры. Пораженные листья черемухи покрываются сначала беловатыми, впоследствии фиолетового или буровато-малинового цвета угловатыми пятнами. Такие листья преждевременно опадают, а весной осенние перезимовавшие на опавших листьях споры прорастают в новое спороношение, которое заражает шишки ели. Подобный цикл развития имеет и другой возбудитель ржавчины шишек — хризомикса грушанки. Оба возбудителя легко различимы. Последний на кроющих чешуйках шишек образует два крупных оранжевого цвета весенних споровместилища. Промежуточный хозяин этого гриба — грушанки. Грушанки интересны тем, что листья у них круглый год зеленые. В таких листьях и зимует мицелий гриба с осенними спорами. Летом можно найти экземпляры грушанок, прошлогодние листья которых засохли в результате поражения грибом, а на новых листочках заметны яркие оранжевые пустулы гриба — результат заражения текущего года. Зараженные грушанки не образуют стройных цветоносов с белоснежными цветами.
 Ржавчина шишек ели. Эцидии на чешуйках шишек. Гриб имеет второе название — текопсора черемуховая, так как его второй хозяин — черемуха
В пораженных ржавчиной шишках развиваются немногочисленные щуплые, мелкие, с низкой всхожестью семена.
Ржавчина шишек ели. Эцидии на чешуйках шишек. Гриб имеет второе название — текопсора черемуховая, так как его второй хозяин — черемуха
В пораженных ржавчиной шишках развиваются немногочисленные щуплые, мелкие, с низкой всхожестью семена.
 Первое спороношение — эцидий в цикле развития ржавчинного гриба образуется на чешуйках шишек ели; второй хозяин этого гриба — грушанка
Во влажные годы на крылатках различных видов ясеня и клена, желудях дуба, плодах ореха, реже на семенах других пород заметны различной формы и цвета пятна с развивающимися на них спороношениями грибов — возбудителей пятнистостей. Ими могут быть:
• гифомицеты (например, церкоспора клена образует на его крылатках черноватые пятна с пучками конидиеносцев и конидиями оливкового цвета);
• известны пятнистости, вызываемые меланкониальными грибами из родов глоеоспориум и цилиндроспориум;
• пикнидиальными грибами из родов фома, аскохита, диплодина, филлостикта и др.;
• сумчатые грибы (ритисма клена на крылатках клена).
Многие возбудители болезней плодов и семян способны продолжать развитие на семенах при хранении их и транспортировке, на сеянцах и даже на взрослых растениях, ослабляя их и вызывая гибель всего дерева или отдельных его органов.
Особенно большой вред при транспортировке и хранении плодов и семян лесных пород приносят возбудители плесневения. Плесень проявляется на поверхности зараженных плодов и семян в виде различных оттенков зеленого цвета, порошащих (ее образуют разные виды родов пенициллиум, аспергиллус, триходерма и др.), темно-бурых или оливково-черных сажистых (разные виды родов альтернария, аспергиллус, кладоспориум и др.), розоватых (виды рода трихотециум) налетов и дерновинок, беловато-серого паутинистого мицелия с очень мелкими черными головками мукоровых грибов. Пронизывая мицелием растительную ткань, они значительно снижают жизнеспособность и всхожесть плодов и семян. Многие из грибов — возбудителей плесени продолжают свое развитие на всходах, саженцах, сеянцах, вызывая повреждение корневой системы, что приводит к преждевременной гибели растений.
Многие из микромицетов, вызывающих плесневение плодов и семян, — постоянные обитатели почвы и подстилки. В условиях неблагоприятных для прорастания семян они могут задерживать процесс развития проростков, ограничивая появление в лесах подроста.
Грибы поражают растения на разных стадиях развития. Многие болезни, вызываемые микромицетами, являются специфичными для определенных возрастных групп лесных растений. Например, характерное для начальной фазы развития растений полегание всходов, выражается в поражении неокрепшей корневой шейки. В этот период всходы лесных пород находятся в травянистом состоянии и подвергаются нападению грибов.
В почвах лесных питомников, расположенных на площадках бывших сельскохозяйственных угодий, содержится гриб из рода фузариум — один из основных возбудителей полегания сеянцев сосны, особенно в бассейне оз. Байкал. Многие виды рода фузариум — полифаги, т. е. поражают различные растения. При длительном возделывании на одной и той же площади восприимчивых к этим грибам растений инфекция накапливается в почве. В таких питомниках чаще наблюдается и выпревание сеянцев, вызываемое микромицетом — склеротинией злаков. В активе этого гриба, кроме сеянцев лесных пород, культурные и дикорастущие злаки. Выпревание может вызвать и базидиомицет — тифуля злаков, поражающая многие злаки. Оба возбудителя обнаруживаются сразу же после таяния снега по мицелиальным пленкам, опутывающим сеянцы с поникшими хвоинками. Мицелий тифули сероватого цвета, а склеротинии белоснежный. В цикле развития обоих возбудителей имеются склероции, которые в течение лета опадают на землю с хвоинок, из пазух хвои, со стволиков и осенью прорастают. Спороношения этих грибов заражают растения. Заболевание может встречаться и на самосеве, что снижает естественное возобновление леса.
Первое спороношение — эцидий в цикле развития ржавчинного гриба образуется на чешуйках шишек ели; второй хозяин этого гриба — грушанка
Во влажные годы на крылатках различных видов ясеня и клена, желудях дуба, плодах ореха, реже на семенах других пород заметны различной формы и цвета пятна с развивающимися на них спороношениями грибов — возбудителей пятнистостей. Ими могут быть:
• гифомицеты (например, церкоспора клена образует на его крылатках черноватые пятна с пучками конидиеносцев и конидиями оливкового цвета);
• известны пятнистости, вызываемые меланкониальными грибами из родов глоеоспориум и цилиндроспориум;
• пикнидиальными грибами из родов фома, аскохита, диплодина, филлостикта и др.;
• сумчатые грибы (ритисма клена на крылатках клена).
Многие возбудители болезней плодов и семян способны продолжать развитие на семенах при хранении их и транспортировке, на сеянцах и даже на взрослых растениях, ослабляя их и вызывая гибель всего дерева или отдельных его органов.
Особенно большой вред при транспортировке и хранении плодов и семян лесных пород приносят возбудители плесневения. Плесень проявляется на поверхности зараженных плодов и семян в виде различных оттенков зеленого цвета, порошащих (ее образуют разные виды родов пенициллиум, аспергиллус, триходерма и др.), темно-бурых или оливково-черных сажистых (разные виды родов альтернария, аспергиллус, кладоспориум и др.), розоватых (виды рода трихотециум) налетов и дерновинок, беловато-серого паутинистого мицелия с очень мелкими черными головками мукоровых грибов. Пронизывая мицелием растительную ткань, они значительно снижают жизнеспособность и всхожесть плодов и семян. Многие из грибов — возбудителей плесени продолжают свое развитие на всходах, саженцах, сеянцах, вызывая повреждение корневой системы, что приводит к преждевременной гибели растений.
Многие из микромицетов, вызывающих плесневение плодов и семян, — постоянные обитатели почвы и подстилки. В условиях неблагоприятных для прорастания семян они могут задерживать процесс развития проростков, ограничивая появление в лесах подроста.
Грибы поражают растения на разных стадиях развития. Многие болезни, вызываемые микромицетами, являются специфичными для определенных возрастных групп лесных растений. Например, характерное для начальной фазы развития растений полегание всходов, выражается в поражении неокрепшей корневой шейки. В этот период всходы лесных пород находятся в травянистом состоянии и подвергаются нападению грибов.
В почвах лесных питомников, расположенных на площадках бывших сельскохозяйственных угодий, содержится гриб из рода фузариум — один из основных возбудителей полегания сеянцев сосны, особенно в бассейне оз. Байкал. Многие виды рода фузариум — полифаги, т. е. поражают различные растения. При длительном возделывании на одной и той же площади восприимчивых к этим грибам растений инфекция накапливается в почве. В таких питомниках чаще наблюдается и выпревание сеянцев, вызываемое микромицетом — склеротинией злаков. В активе этого гриба, кроме сеянцев лесных пород, культурные и дикорастущие злаки. Выпревание может вызвать и базидиомицет — тифуля злаков, поражающая многие злаки. Оба возбудителя обнаруживаются сразу же после таяния снега по мицелиальным пленкам, опутывающим сеянцы с поникшими хвоинками. Мицелий тифули сероватого цвета, а склеротинии белоснежный. В цикле развития обоих возбудителей имеются склероции, которые в течение лета опадают на землю с хвоинок, из пазух хвои, со стволиков и осенью прорастают. Спороношения этих грибов заражают растения. Заболевание может встречаться и на самосеве, что снижает естественное возобновление леса.
 Обыкновенное шютте сосны: а — пораженный грибом сеянец; б — пятнистость на хвое; в — апотеции(плодовые тела гриба) на хвое
Если возбудители выпревания поражают однолетние и двухлетние сеянцы, то болезни типа шютте известны и на молодых, и на взрослых растениях. Они проявляются в изменении окраски хвои, ее отмирании и преждевременном опадании. Пораженная хвоя — сероватого цвета, с черными бугорками спороношений грибов. Особенно заметны такие опавшие хвоинки зимой, на белоснежном покрывале снега. Заболеванию подвержены хвойные породы — сосна обыкновенная, кедр сибирский, ель, пихта и др. Возбудители заболевания — дискомицеты из родов лофодермиум, фацидиум и др. Шютте лиственницы вызывает гифомицет мерия лиственницы.
Отличительным признаком заболевания обыкновенного шютте сосны (возбудитель лофодермиум сосновый) является наличие темных поперечных линий на хвое, разделяющих поверхность хвоинок на прямоугольники или квадраты. На таких хвоинках заметны очень мелкие и более крупные спороношения гриба. Гриб распространяется аскоспорами. Они разлетаются в течение длительного периода, но максимум разлета приходится на весенне-летний и осенний период; В связи с тем, что возбудитель обладает огромной споро-образующей способностью, часто наблюдаются эпифитотии — заболевания, при которых гибнут деревья сосны главным образом в возрасте до 3 лет. Более взрослые деревья меньше страдают от этой болезни.
Обыкновенное шютте сосны: а — пораженный грибом сеянец; б — пятнистость на хвое; в — апотеции(плодовые тела гриба) на хвое
Если возбудители выпревания поражают однолетние и двухлетние сеянцы, то болезни типа шютте известны и на молодых, и на взрослых растениях. Они проявляются в изменении окраски хвои, ее отмирании и преждевременном опадании. Пораженная хвоя — сероватого цвета, с черными бугорками спороношений грибов. Особенно заметны такие опавшие хвоинки зимой, на белоснежном покрывале снега. Заболеванию подвержены хвойные породы — сосна обыкновенная, кедр сибирский, ель, пихта и др. Возбудители заболевания — дискомицеты из родов лофодермиум, фацидиум и др. Шютте лиственницы вызывает гифомицет мерия лиственницы.
Отличительным признаком заболевания обыкновенного шютте сосны (возбудитель лофодермиум сосновый) является наличие темных поперечных линий на хвое, разделяющих поверхность хвоинок на прямоугольники или квадраты. На таких хвоинках заметны очень мелкие и более крупные спороношения гриба. Гриб распространяется аскоспорами. Они разлетаются в течение длительного периода, но максимум разлета приходится на весенне-летний и осенний период; В связи с тем, что возбудитель обладает огромной споро-образующей способностью, часто наблюдаются эпифитотии — заболевания, при которых гибнут деревья сосны главным образом в возрасте до 3 лет. Более взрослые деревья меньше страдают от этой болезни.
 Черная пятнистость листьев клена, вызываемая грибом ритизмой(зимующая стадия)
Возбудитель заболевания снежного шютте сосны — фацидиум инфестанс — ведет более активный образ жизни, иногда его называют снежным грибом. Гриб получил такое название за способность развиваться при низких температурах, от 0 до -5°С, под снежным покровом. Если в январе выкопать пораженное снежным шютте деревце сосны, то на его хвое можно заметить темный паутинистый мицелий. Под снегом заболевшая хвоя изменяет окраску от нормальной зеленой до мраморной, состоящей из участков зеленого, желтого и коричневого цвета. В первые дни после таяния снега на деревцах заметна паутинистая серовато-белая грибница, обволакивающая больные веточки и сохраняющаяся непродолжительное время. Погибшие растения выделяются куртинами рыжеватого цвета из-за отмершей хвои. Впоследствии на ней развиваются плодовые тела гриба (апотеции) со спорами, хвоя становится серого цвета. При рассматривании в бинокуляр раскрывшиеся плодовые тела выглядят сказочными цветами: черные лепестки — лопасти лопнувшей оболочки — обрамляют серовато-розовую сердцевину, где находятся споры. Рассеивание спор гриба и заражение ими растений зависит от многих причин и прежде всего от погодных условий.
Микромицеты способны развиваться и на деревьях более старшего возраста. Правда, вред от них взрослым растениям не столь ощутим, хотя и они могут вызвать преждевременное засыхание и опадение листьев и хвои, отмирание отдельных участков коры, усыхание всего дерева или отдельных участков кроны.
Черная пятнистость листьев клена, вызываемая грибом ритизмой(зимующая стадия)
Возбудитель заболевания снежного шютте сосны — фацидиум инфестанс — ведет более активный образ жизни, иногда его называют снежным грибом. Гриб получил такое название за способность развиваться при низких температурах, от 0 до -5°С, под снежным покровом. Если в январе выкопать пораженное снежным шютте деревце сосны, то на его хвое можно заметить темный паутинистый мицелий. Под снегом заболевшая хвоя изменяет окраску от нормальной зеленой до мраморной, состоящей из участков зеленого, желтого и коричневого цвета. В первые дни после таяния снега на деревцах заметна паутинистая серовато-белая грибница, обволакивающая больные веточки и сохраняющаяся непродолжительное время. Погибшие растения выделяются куртинами рыжеватого цвета из-за отмершей хвои. Впоследствии на ней развиваются плодовые тела гриба (апотеции) со спорами, хвоя становится серого цвета. При рассматривании в бинокуляр раскрывшиеся плодовые тела выглядят сказочными цветами: черные лепестки — лопасти лопнувшей оболочки — обрамляют серовато-розовую сердцевину, где находятся споры. Рассеивание спор гриба и заражение ими растений зависит от многих причин и прежде всего от погодных условий.
Микромицеты способны развиваться и на деревьях более старшего возраста. Правда, вред от них взрослым растениям не столь ощутим, хотя и они могут вызвать преждевременное засыхание и опадение листьев и хвои, отмирание отдельных участков коры, усыхание всего дерева или отдельных участков кроны.
 Ритизма ивы. Так выглядит микроскопическое строение этого гриба по рисунку из книги братьев Тюлянь
Часто осенью на опавших разноцветных листьях клена мы замечаем крупные, выпуклые, блестящие, черные пятна, окруженные желто-зеленой каймой. Это — результат поражения листьев грибом ритисмой клена — виновником черной пятнистости листьев и семян клена. Мицелий гриба пронизывает клетки поверхности листа и разрушает их стенки, сплетаясь в сплошную плоскую строму. Во второй половине лета строма утолщается, чернеет, приобретает характер склероциев. В них закладываются полости — будущие плодовые тела (апотеции), заканчивающие формирование к весне будущего года на опавших листьях. В них формируются сумки с вытянутыми нитевидными спорами. Споры заражают молодые листья клена, молодые крылатки, вызывая пятнистости. У многих грибов обычно бывает по две стадии: летняя (конидиальная), служащая для распространения заболевания в течение лета, для захвата все большего числа растений-хозяев, и позднелетняя или осенняя (сумчатая), которая уже перезимовывает и весной вновь заражает растения уже аско- или сумкоспорами.
Парша, возбудителем которой является гриб из рода поллачия, часто поражает тополь и осину. На зараженных листьях конидиальная стадия образует бархатистые оливкового цвета налеты. Они — агенты распространения гриба летом во время вегетационного периода. Первичное заражение осуществляется весной аскоспорами, развивающимися в плодовых телах на перезимовавших листьях. Кроме листьев, грибы поражают и молодые побеги, которые чернеют, характерно загибаясь крючком, и поникают. Во влажную погоду заболевание прогрессирует и сопровождается опадением листьев.
Заболевание ассимилирующих органов деревьев и кустарников разного возраста часто вызывают ржавчинные грибы. Они резко ослабляют фотосинтезирующую активность листьев и хвои, и те преждевременно опадают. Основные ржавчинники, паразитирующие на хвое и листьях, — разнохозяинные формы. Многие из них характеризуются полным циклом развития. Он свойствен, например, видам родов колеоспориум — виновникам ржавчины хвои сосны, мелампсоре — возбудителю соснового вертуна, мелампсоридиум — возбудителю ржавчины листьев березы и лиственницы. У всех названных возбудителей два весенних спороношения развиваются на хвойных породах, а летнее и осеннее на промежуточных хозяевах, специфичных для каждого вида ржавчинного гриба. Для разных видов рода колеоспориум промежуточными хозяевами являются мать-и-мачеха, осот, разные виды колокольчиков; для возбудителя соснового вертуна — листья осины и т. д.
Из ржавчин, поражающих вегетирующие органы хвойных пород, наиболее вредоносно заболевание сосновый вертун. Им заражаются сосны всех возрастов, но наибольшую опасность он представляет для 2-10-летних деревьев. Кроме хвои, поражаются ветви — они искривляются.
На листьях и неодревесневших побегах часто можно рассмотреть паутинистую, рыхлую грибницу, которая впоследствии покрывается мучнистым налетом от развивающихся конидий. Это признак заболевания растений. Болезнь называется мучнистая роса. Пораженные ею молодые побеги деформируются, искривляются, листья скручиваются. Возбудители мучнистой росы — мучнисторосяные грибы. Разные виды этих грибов имеют сходный цикл развития. На протяжении вегетационного периода рыхлый мицелий постепенно уплотняется и иногда коричневеет. Конидиальная стадия, которая у всех видов мучнисторосяных грибов одинакова (на цилиндрических конидиеносцах цепочкой развиваются споры), сменяется сумчатой стадией. Если в конидиальной стадии мучнисторосяные грибы трудно отличить даже при рассматривании в микроскоп, то в сумчатой стадии их легко различить по строению отростков на плодовых телах и по количеству сумок в них. Зимуют мучнисторосяные грибы чаще на опавших листьях или на пораженных побегах, а иногда и в почках заболевших органов. Весной после созревания сумок и разрушения плодовых тел сумкоспоры заражают растения.
Поражение мучнистой росой задерживает одревеснение побегов и способствует их отмиранию после ранних осенних заморозков и зимой. Наиболее широко распространена мучнистая роса дуба. Этому заболеванию подвержены также деревья и кустарники, применяемые для озеленения городов и поселков, — тополя, ивы, боярышник и др.
Ритизма ивы. Так выглядит микроскопическое строение этого гриба по рисунку из книги братьев Тюлянь
Часто осенью на опавших разноцветных листьях клена мы замечаем крупные, выпуклые, блестящие, черные пятна, окруженные желто-зеленой каймой. Это — результат поражения листьев грибом ритисмой клена — виновником черной пятнистости листьев и семян клена. Мицелий гриба пронизывает клетки поверхности листа и разрушает их стенки, сплетаясь в сплошную плоскую строму. Во второй половине лета строма утолщается, чернеет, приобретает характер склероциев. В них закладываются полости — будущие плодовые тела (апотеции), заканчивающие формирование к весне будущего года на опавших листьях. В них формируются сумки с вытянутыми нитевидными спорами. Споры заражают молодые листья клена, молодые крылатки, вызывая пятнистости. У многих грибов обычно бывает по две стадии: летняя (конидиальная), служащая для распространения заболевания в течение лета, для захвата все большего числа растений-хозяев, и позднелетняя или осенняя (сумчатая), которая уже перезимовывает и весной вновь заражает растения уже аско- или сумкоспорами.
Парша, возбудителем которой является гриб из рода поллачия, часто поражает тополь и осину. На зараженных листьях конидиальная стадия образует бархатистые оливкового цвета налеты. Они — агенты распространения гриба летом во время вегетационного периода. Первичное заражение осуществляется весной аскоспорами, развивающимися в плодовых телах на перезимовавших листьях. Кроме листьев, грибы поражают и молодые побеги, которые чернеют, характерно загибаясь крючком, и поникают. Во влажную погоду заболевание прогрессирует и сопровождается опадением листьев.
Заболевание ассимилирующих органов деревьев и кустарников разного возраста часто вызывают ржавчинные грибы. Они резко ослабляют фотосинтезирующую активность листьев и хвои, и те преждевременно опадают. Основные ржавчинники, паразитирующие на хвое и листьях, — разнохозяинные формы. Многие из них характеризуются полным циклом развития. Он свойствен, например, видам родов колеоспориум — виновникам ржавчины хвои сосны, мелампсоре — возбудителю соснового вертуна, мелампсоридиум — возбудителю ржавчины листьев березы и лиственницы. У всех названных возбудителей два весенних спороношения развиваются на хвойных породах, а летнее и осеннее на промежуточных хозяевах, специфичных для каждого вида ржавчинного гриба. Для разных видов рода колеоспориум промежуточными хозяевами являются мать-и-мачеха, осот, разные виды колокольчиков; для возбудителя соснового вертуна — листья осины и т. д.
Из ржавчин, поражающих вегетирующие органы хвойных пород, наиболее вредоносно заболевание сосновый вертун. Им заражаются сосны всех возрастов, но наибольшую опасность он представляет для 2-10-летних деревьев. Кроме хвои, поражаются ветви — они искривляются.
На листьях и неодревесневших побегах часто можно рассмотреть паутинистую, рыхлую грибницу, которая впоследствии покрывается мучнистым налетом от развивающихся конидий. Это признак заболевания растений. Болезнь называется мучнистая роса. Пораженные ею молодые побеги деформируются, искривляются, листья скручиваются. Возбудители мучнистой росы — мучнисторосяные грибы. Разные виды этих грибов имеют сходный цикл развития. На протяжении вегетационного периода рыхлый мицелий постепенно уплотняется и иногда коричневеет. Конидиальная стадия, которая у всех видов мучнисторосяных грибов одинакова (на цилиндрических конидиеносцах цепочкой развиваются споры), сменяется сумчатой стадией. Если в конидиальной стадии мучнисторосяные грибы трудно отличить даже при рассматривании в микроскоп, то в сумчатой стадии их легко различить по строению отростков на плодовых телах и по количеству сумок в них. Зимуют мучнисторосяные грибы чаще на опавших листьях или на пораженных побегах, а иногда и в почках заболевших органов. Весной после созревания сумок и разрушения плодовых тел сумкоспоры заражают растения.
Поражение мучнистой росой задерживает одревеснение побегов и способствует их отмиранию после ранних осенних заморозков и зимой. Наиболее широко распространена мучнистая роса дуба. Этому заболеванию подвержены также деревья и кустарники, применяемые для озеленения городов и поселков, — тополя, ивы, боярышник и др.
 Мучнисторосяный гриб на листьях клена ясенелистного
Еще более сильное воздействие на древесные породы молодого и зрелого возраста оказывают микромицеты — возбудители сосудистых заболеваний. Они вызывают увядание или усыхание всей кроны или ее отдельных частей вследствие поражения проводящей системы, что проявляется в потемнении сосудов (на поперечных срезах заболевших ветвей, стволов оно заметно в виде сплошных полей, а на продольных — в виде прерывистых линий). Потемнение сосудов — результат жизнедеятельности мицелия возбудителя. Грибница может проникать в сосуды, и в них образуется черное камедеобразное вещество, препятствующее нормальному функционированию сосудистой системы.
Мучнисторосяный гриб на листьях клена ясенелистного
Еще более сильное воздействие на древесные породы молодого и зрелого возраста оказывают микромицеты — возбудители сосудистых заболеваний. Они вызывают увядание или усыхание всей кроны или ее отдельных частей вследствие поражения проводящей системы, что проявляется в потемнении сосудов (на поперечных срезах заболевших ветвей, стволов оно заметно в виде сплошных полей, а на продольных — в виде прерывистых линий). Потемнение сосудов — результат жизнедеятельности мицелия возбудителя. Грибница может проникать в сосуды, и в них образуется черное камедеобразное вещество, препятствующее нормальному функционированию сосудистой системы.
 Цепочка конидий и плодовые тела(клейстотеции) возбудителя мучнистой росы дуба — микросферы
Возбудителями сосудистых заболеваний древесных пород являются несколько видов микромицетов из разных таксономических групп, главным образом гифомицеты и пикнидиальные грибы.
Цепочка конидий и плодовые тела(клейстотеции) возбудителя мучнистой росы дуба — микросферы
Возбудителями сосудистых заболеваний древесных пород являются несколько видов микромицетов из разных таксономических групп, главным образом гифомицеты и пикнидиальные грибы.
 Листья дуба, пораженные мучнистой росой
Возбудители вертициллезного вилта — грибы из рода вертициллиум могут поражать лиственные породы (клен, липу, конский каштан, шелковицу и др.), свыше 350 видов травянистых растений, кустарников. По паразитическим свойствам виды этого рода — факультативные сапротрофы. В цикле развития чередуются вегетативный рост мицелия, размножение при помощи конидий, развивающихся на мутовчато ветвящихся конидиеносцах, и покоящиеся стадии. При наступлении благоприятных условий покоящиеся структуры прорастают мицелием, на котором формируются конидиеносцы с конидиями. Возбудители вертициллезного вилта — обитатели почвы и внедряются в корни деревьев и кустарников через корни, поражают сосуды по которым распространяется не только мицелий, но и конидии. Наиболее подвержен вилту клен. Сосудистое увядание дубов и каштанов, вызываемое грибами из рода цератоцистис, распространено в США, где оно зарегистрировано на территории 18 штатов, а в числе поражаемых видов — каштан съедобный и все 28 видов дубов, произрастающих на территории Америки.
Возбудители некрозо-раковых заболеваний древесных пород. Возбудители этих заболеваний — в основном микромицеты.
Одни из наиболее распространенных возбудителей некрозных заболеваний древесных пород — грибы рода цитоспора. Их насчитывается 19 видов, и все они живут на мертвых тканях, являющихся частью живых растений. Эти некрозы — заболевания, известные под разными названиями: цитоспороз, цитоспорозное усыхание, цитоспорозный рак, апоплексия и др. Грибы рода цитоспора — слабые паразиты, агрессивность которых усиливается на ослабленных деревьях. Интересные наблюдения проведены по зависимости развития цитоспоры от повреждения огнем деревьев во время пожара. Оказалось, что заболевание сильнее проявляется на деревьях, перенесших огневой стресс. То же справедливо и для экземпляров деревьев, подвергшихся стрессам, связанным с дефицитом воды, воздействием низких температур и т. д. Грибы рода цитоспора поражают и желуди, понижая их всхожесть, встречаются на ветвях, коре стволов и скелетных ветвей дуба и многих других лиственных пород. Наиболее часто эти микромицеты поселяются на разных видах дуба, тополя, плодовых пород (дикорастущих и культурных). При некрозах поражаются кора, луб, камбий и наружные слои древесины, кора при этом часто отслаивается. Молодые деревца могут погибнуть, а взрослые растения служат источником инфекции.
Цитоспороз отличим от других заболеваний коры по выходящим во влажную погоду из особых шаровидных споровместилищ (пикнид) конидий, погруженных в слизь. Часто они застывают на воздухе и заметны на коре пораженных органов в виде спиралей, усиков или капель благодаря их окраске. Цвет слизи зависит от пигментов, выделяемых грибами, и бывает кремовым, бледно-желтым, оранжево-красным, темно-красным и черным. Кроме пигментов, в слизи пикнидиальных грибов обнаружены моносахара, полисахариды, аминокислоты, вода. Роль слизи в жизни этих грибов многообразна. Она защищает конидии от губительного действия солнечных лучей благодаря наличию пигментов. Моносахара, полисахариды и аминокислоты служат прорастающим конидиям питательным субстратом. Слизь облегчает распространение конидий потоками воздуха: слипшиеся в небольшие комочки, подсохшие, они легче подхватываются воздушными течениями и переносятся на другие деревья. При распространении с каплями дождя многие компоненты слизи быстро растворяются в воде, и этот раствор тоже может служить питательным субстратом для прорастающих конидий. Слизь облегчает и разнос конидий насекомыми. Грибы рода цитоспора образуют огромное количество конидий. Подсчитано, например, что на поверхности 30 см2 ветвей тополя число конидий около 25 млрд., а в одной пикниде до 400 млн.
Кроме цитоспороза, известны и другие некрозы, вызываемые иными видами пикнидиальных грибов. Например, один из грибов-возбудителей дотихица вызывает локальные, или круговые, некрозы стволов и ветвей тополя, выделяющиеся на живой коре вначале темным, а затем желтоватым цветом. Иногда одновременно с некрозами на больных деревьях можно заметить и раковые раны. Чаще они появляются при поражении толстых стволов, в которых мицелий развивается несколько лет. На отмерших и отмирающих участках коры образуются споровместилища (пикниды) возбудителя, из которых выходят конидии в виде черновато-белых или светло-оливковых жгутов. Они придают сероватый оттенок пораженным участкам стволов и ветвей.
Болезни типа некрозов вызывают и сумчатые грибы. Известен клитрусовый некроз дуба, выражающийся в образовании на коре дуба сначала красноватых, потом желтовато-беловатых некротических участков, резко отличающихся от здоровой коры. Возбудитель — сумчатый гриб клитрус дубовый. На пораженной ткани бывают хорошо различимы ярко-розовые и светло-красные подушечки, выступающие из трещин коры. Это спороношения возбудителей нектриевых некрозов лиственных и хвойных пород. Спороношения образуются круглый год, поэтому и привлекают глаз человека. Проникая через ранки и другие механические повреждения, грибы вызывают усыхание ветвей главным образом ослабленных деревьев. Иногда этих возбудителей называют раневыми паразитами за их способность проникать через раны внутрь стволов и ветвей.
Листья дуба, пораженные мучнистой росой
Возбудители вертициллезного вилта — грибы из рода вертициллиум могут поражать лиственные породы (клен, липу, конский каштан, шелковицу и др.), свыше 350 видов травянистых растений, кустарников. По паразитическим свойствам виды этого рода — факультативные сапротрофы. В цикле развития чередуются вегетативный рост мицелия, размножение при помощи конидий, развивающихся на мутовчато ветвящихся конидиеносцах, и покоящиеся стадии. При наступлении благоприятных условий покоящиеся структуры прорастают мицелием, на котором формируются конидиеносцы с конидиями. Возбудители вертициллезного вилта — обитатели почвы и внедряются в корни деревьев и кустарников через корни, поражают сосуды по которым распространяется не только мицелий, но и конидии. Наиболее подвержен вилту клен. Сосудистое увядание дубов и каштанов, вызываемое грибами из рода цератоцистис, распространено в США, где оно зарегистрировано на территории 18 штатов, а в числе поражаемых видов — каштан съедобный и все 28 видов дубов, произрастающих на территории Америки.
Возбудители некрозо-раковых заболеваний древесных пород. Возбудители этих заболеваний — в основном микромицеты.
Одни из наиболее распространенных возбудителей некрозных заболеваний древесных пород — грибы рода цитоспора. Их насчитывается 19 видов, и все они живут на мертвых тканях, являющихся частью живых растений. Эти некрозы — заболевания, известные под разными названиями: цитоспороз, цитоспорозное усыхание, цитоспорозный рак, апоплексия и др. Грибы рода цитоспора — слабые паразиты, агрессивность которых усиливается на ослабленных деревьях. Интересные наблюдения проведены по зависимости развития цитоспоры от повреждения огнем деревьев во время пожара. Оказалось, что заболевание сильнее проявляется на деревьях, перенесших огневой стресс. То же справедливо и для экземпляров деревьев, подвергшихся стрессам, связанным с дефицитом воды, воздействием низких температур и т. д. Грибы рода цитоспора поражают и желуди, понижая их всхожесть, встречаются на ветвях, коре стволов и скелетных ветвей дуба и многих других лиственных пород. Наиболее часто эти микромицеты поселяются на разных видах дуба, тополя, плодовых пород (дикорастущих и культурных). При некрозах поражаются кора, луб, камбий и наружные слои древесины, кора при этом часто отслаивается. Молодые деревца могут погибнуть, а взрослые растения служат источником инфекции.
Цитоспороз отличим от других заболеваний коры по выходящим во влажную погоду из особых шаровидных споровместилищ (пикнид) конидий, погруженных в слизь. Часто они застывают на воздухе и заметны на коре пораженных органов в виде спиралей, усиков или капель благодаря их окраске. Цвет слизи зависит от пигментов, выделяемых грибами, и бывает кремовым, бледно-желтым, оранжево-красным, темно-красным и черным. Кроме пигментов, в слизи пикнидиальных грибов обнаружены моносахара, полисахариды, аминокислоты, вода. Роль слизи в жизни этих грибов многообразна. Она защищает конидии от губительного действия солнечных лучей благодаря наличию пигментов. Моносахара, полисахариды и аминокислоты служат прорастающим конидиям питательным субстратом. Слизь облегчает распространение конидий потоками воздуха: слипшиеся в небольшие комочки, подсохшие, они легче подхватываются воздушными течениями и переносятся на другие деревья. При распространении с каплями дождя многие компоненты слизи быстро растворяются в воде, и этот раствор тоже может служить питательным субстратом для прорастающих конидий. Слизь облегчает и разнос конидий насекомыми. Грибы рода цитоспора образуют огромное количество конидий. Подсчитано, например, что на поверхности 30 см2 ветвей тополя число конидий около 25 млрд., а в одной пикниде до 400 млн.
Кроме цитоспороза, известны и другие некрозы, вызываемые иными видами пикнидиальных грибов. Например, один из грибов-возбудителей дотихица вызывает локальные, или круговые, некрозы стволов и ветвей тополя, выделяющиеся на живой коре вначале темным, а затем желтоватым цветом. Иногда одновременно с некрозами на больных деревьях можно заметить и раковые раны. Чаще они появляются при поражении толстых стволов, в которых мицелий развивается несколько лет. На отмерших и отмирающих участках коры образуются споровместилища (пикниды) возбудителя, из которых выходят конидии в виде черновато-белых или светло-оливковых жгутов. Они придают сероватый оттенок пораженным участкам стволов и ветвей.
Болезни типа некрозов вызывают и сумчатые грибы. Известен клитрусовый некроз дуба, выражающийся в образовании на коре дуба сначала красноватых, потом желтовато-беловатых некротических участков, резко отличающихся от здоровой коры. Возбудитель — сумчатый гриб клитрус дубовый. На пораженной ткани бывают хорошо различимы ярко-розовые и светло-красные подушечки, выступающие из трещин коры. Это спороношения возбудителей нектриевых некрозов лиственных и хвойных пород. Спороношения образуются круглый год, поэтому и привлекают глаз человека. Проникая через ранки и другие механические повреждения, грибы вызывают усыхание ветвей главным образом ослабленных деревьев. Иногда этих возбудителей называют раневыми паразитами за их способность проникать через раны внутрь стволов и ветвей.
 Клитрусовый некроз дуба. Плодовые тела гриба — апотеции
При раковых болезнях процесс разрушения тканей дерева протекает в течение многих лет, захватывая кору, луб, камбий и древесину. В зависимости от внешних признаков и характера поражения различают несколько типов раковых болезней:
• язвенную,
• ступенчатую,
• опухолевидную,
• мокрый рак.
Ржавчинные грибы — возбудители рака хвойных пород — относятся к разным родам. Два вида, кронарциум поникший и перидермиум сосновый, вызывают смоляной рак (серянку) сосны. Основной признак этого заболевания — смолотечение, возникающее в результате проникновения мицелия в клетки древесины и смоляные ходы. Смола, вытекая из ран, застывает в виде серовато-желтых бугорков, желваков или подтеков. Пораженная кора шелушится и опадает. Мицелий, распространяющийся в пораженных участках ветвей, стволов, воздействует на нормальное распределение питательных веществ, что нарушает рост годичных колец, и заболевшие органы дерева деформируются.
Клитрусовый некроз дуба. Плодовые тела гриба — апотеции
При раковых болезнях процесс разрушения тканей дерева протекает в течение многих лет, захватывая кору, луб, камбий и древесину. В зависимости от внешних признаков и характера поражения различают несколько типов раковых болезней:
• язвенную,
• ступенчатую,
• опухолевидную,
• мокрый рак.
Ржавчинные грибы — возбудители рака хвойных пород — относятся к разным родам. Два вида, кронарциум поникший и перидермиум сосновый, вызывают смоляной рак (серянку) сосны. Основной признак этого заболевания — смолотечение, возникающее в результате проникновения мицелия в клетки древесины и смоляные ходы. Смола, вытекая из ран, застывает в виде серовато-желтых бугорков, желваков или подтеков. Пораженная кора шелушится и опадает. Мицелий, распространяющийся в пораженных участках ветвей, стволов, воздействует на нормальное распределение питательных веществ, что нарушает рост годичных колец, и заболевшие органы дерева деформируются.
 Спороношение нектрии киноварно-красной на засохших ветвях
Возбудитель ржавчинного рака пихты вызывает на пораженном дереве опухоли и ведьмины метлы (сильно разветвленные побеги). Цикл развития возбудителя протекает на пихте и различных растениях семейства гвоздичных. При заражении молодых побегов и ветвей пихты сначала образуются муфтовидные наросты; на следующую весну из почек таких ветвей вырастают вертикально направленные побеги, развивающиеся в ведьмины метлы. На хвое таких побегов весной образуются спороношения гриба-возбудителя, а зимой хвоя с таких побегов опадает, и ведьмины метлы в это время лучше заметны. При проникновении мицелия в камбий и его отмирании у основания ведьминых метел возникают раковые образования.
Сумчатый гриб нектрия галлообразующая заражает клен, бук, дуб, граб и многие плодовые породы. Под его действием камбий отмирает, а прилегающие к ране клетки здоровых тканей начинают делиться, вследствие чего вокруг раны образуются наплывы в виде валика (галла). Количество валиков ежегодно увеличивается, и рана разрастается, принимая форму ступени. Другие виды рода нектрия вызывают некрозы.
От расположения раковых ран на стволе зависит состояние дерева. Наиболее опасны раны в подкроновой части, так как они часто приводят к отмиранию вершины. Раны, трещины служат воротами инфекции для грибов, вызывающих гниль древесины. Живые участки древесины около ран заселяются стволовыми вредителями.
Насекомые являются переносчиками многих болезней древесных пород. Вызывая повреждение покровных тканей деревьев и кустарников, они способствуют проникновению через ранки мицелия грибов. Часто споры грибов проникают внутрь дерева вместе с насекомыми, находясь на поверхности их тела. Передвигаясь по своим ходам, насекомые разносят инфекцию по стволам и ветвям. Но споры возбудителей присутствуют не только на покровах, но и в кишечнике насекомых. Попадая на кору или продвигаясь внутри древесины, насекомые вместе с экскрементами выбрасывают не потерявшие жизнеспособность споры фитопатогенных грибов, заражающих деревья. Инфекция может распространяться и листогрызущими насекомыми и мухами. Фитопатогенные грибы разносятся также животными. Доказано, что кроты и мыши — переносчики корневой губки, а белки переносят инфекцию, вызывающую усыхание дуба. Лоси, питающиеся ветками и листьями деревьев и кустарников, открывают тем самым доступ для внедрения раневых паразитов.
Спороношение нектрии киноварно-красной на засохших ветвях
Возбудитель ржавчинного рака пихты вызывает на пораженном дереве опухоли и ведьмины метлы (сильно разветвленные побеги). Цикл развития возбудителя протекает на пихте и различных растениях семейства гвоздичных. При заражении молодых побегов и ветвей пихты сначала образуются муфтовидные наросты; на следующую весну из почек таких ветвей вырастают вертикально направленные побеги, развивающиеся в ведьмины метлы. На хвое таких побегов весной образуются спороношения гриба-возбудителя, а зимой хвоя с таких побегов опадает, и ведьмины метлы в это время лучше заметны. При проникновении мицелия в камбий и его отмирании у основания ведьминых метел возникают раковые образования.
Сумчатый гриб нектрия галлообразующая заражает клен, бук, дуб, граб и многие плодовые породы. Под его действием камбий отмирает, а прилегающие к ране клетки здоровых тканей начинают делиться, вследствие чего вокруг раны образуются наплывы в виде валика (галла). Количество валиков ежегодно увеличивается, и рана разрастается, принимая форму ступени. Другие виды рода нектрия вызывают некрозы.
От расположения раковых ран на стволе зависит состояние дерева. Наиболее опасны раны в подкроновой части, так как они часто приводят к отмиранию вершины. Раны, трещины служат воротами инфекции для грибов, вызывающих гниль древесины. Живые участки древесины около ран заселяются стволовыми вредителями.
Насекомые являются переносчиками многих болезней древесных пород. Вызывая повреждение покровных тканей деревьев и кустарников, они способствуют проникновению через ранки мицелия грибов. Часто споры грибов проникают внутрь дерева вместе с насекомыми, находясь на поверхности их тела. Передвигаясь по своим ходам, насекомые разносят инфекцию по стволам и ветвям. Но споры возбудителей присутствуют не только на покровах, но и в кишечнике насекомых. Попадая на кору или продвигаясь внутри древесины, насекомые вместе с экскрементами выбрасывают не потерявшие жизнеспособность споры фитопатогенных грибов, заражающих деревья. Инфекция может распространяться и листогрызущими насекомыми и мухами. Фитопатогенные грибы разносятся также животными. Доказано, что кроты и мыши — переносчики корневой губки, а белки переносят инфекцию, вызывающую усыхание дуба. Лоси, питающиеся ветками и листьями деревьев и кустарников, открывают тем самым доступ для внедрения раневых паразитов.
Макромицеты — возбудители болезней леса
В нашей стране известно 852 вида грибов-макромицетов древоразрушителей, или ксилотрофов. Большинство их относится к классу базидиомицетов и группе гименомицетов. Многие из них способны развиваться на древесине деревьев, кустарников, хвойных и лиственных пород. Например, в активе настоящего опенка 236 различных пород, но есть грибы и с более узкой специализацией. Иногда на одном и том же дереве уживаются одновременно два и более древоразрушителей. Это свидетельствует о том, что они потребляют из древесины разные питательные вещества или одни и те же, но в последнем случае между ними идет, по-видимому, непримиримая и невидимая для нас борьба за субстрат. Некоторые пластинчатые грибы — чешуйчатки, вешенка легочная, опенок осенний и др. — растут на стволах живых деревьев
Древесные породы заражаются мицелием, развивающимся из попадающих на поверхность коры спор грибов, и проникающим внутрь. Внедрение гриба происходит обычно через разрывы коры или погрызы ее животными, через раны, возникшие под влиянием микромицетов или в результате механических повреждений. Внешние признаки разрушения древесины долго не проявляются; первоначально мицелий разрастается внутри корней, стволов и ветвей, разлагая отдельные слои древесины. Лишь после нескольких месяцев или лет жизнедеятельности мицелия в тканях дерева, кустарника, на стволах, ветвях и корнях появляются однолетние или многолетние плодовые тела макромицетов — разрушителей древесины. Однолетние плодовые тела обычно развиваются во второй половине лета и, окончив спороношение, к зиме отмирают. Во время внезапных первых заморозков плодовые тела на фоне снежной пороши очень эффектны: стоят, как хрустальные, а дотронешься — ломаются, как стекло, обнажая мельчайшие кристаллики льда внутри грибной ткани. При наступлении оттепели некоторые из них, например плодовые тела зимнего гриба, вновь образуют споры. Наиболее выносливы многолетние плодовые тела ксилотрофов: они переживают все невзгоды зимы -и лютые морозы и оттепели. С наступлением весны они оживают и начинают формировать органы спороношения. Одна из морфологических особенностей, позволяющая многолетним плодовым телам древоразрушителей переносить неблагоприятное воздействие внешних условий, — сравнительно толстая пигментированная поверхностная кожица. Она хорошо заметна на поперечном разрезе многих трутовиков. Другая особенность — довольно толстый слой бесплодной ткани, прикрывающий сверху спороносный слой многочисленных древоразрушителей. Главенствующая роль в сохранении жизнеспособности трутовиков принадлежит мицелию. Грибница всех древоразрушителей хорошо защищена от непогоды корой и тканями дерева. Паразиты (биотрофы) из числа грибов-древоразрушителей вместе с живыми тканями дерева вступают в фазу зимнего покоя, а в первые весенние месяцы мицелий вместе с растением-хозяином "просыпается" и, потребляя его питательные вещества, начинает снабжать ими плодовые тела, возобновляющие активную жизнедеятельность. Подобное явление наблюдается и у грибов-ксилосапротрофов, но мицелий их сохраняет жизнеспособность под покровом уже отмерших древесных тканей.
Некоторые пластинчатые грибы — чешуйчатки, вешенка легочная, опенок осенний и др. — растут на стволах живых деревьев
Древесные породы заражаются мицелием, развивающимся из попадающих на поверхность коры спор грибов, и проникающим внутрь. Внедрение гриба происходит обычно через разрывы коры или погрызы ее животными, через раны, возникшие под влиянием микромицетов или в результате механических повреждений. Внешние признаки разрушения древесины долго не проявляются; первоначально мицелий разрастается внутри корней, стволов и ветвей, разлагая отдельные слои древесины. Лишь после нескольких месяцев или лет жизнедеятельности мицелия в тканях дерева, кустарника, на стволах, ветвях и корнях появляются однолетние или многолетние плодовые тела макромицетов — разрушителей древесины. Однолетние плодовые тела обычно развиваются во второй половине лета и, окончив спороношение, к зиме отмирают. Во время внезапных первых заморозков плодовые тела на фоне снежной пороши очень эффектны: стоят, как хрустальные, а дотронешься — ломаются, как стекло, обнажая мельчайшие кристаллики льда внутри грибной ткани. При наступлении оттепели некоторые из них, например плодовые тела зимнего гриба, вновь образуют споры. Наиболее выносливы многолетние плодовые тела ксилотрофов: они переживают все невзгоды зимы -и лютые морозы и оттепели. С наступлением весны они оживают и начинают формировать органы спороношения. Одна из морфологических особенностей, позволяющая многолетним плодовым телам древоразрушителей переносить неблагоприятное воздействие внешних условий, — сравнительно толстая пигментированная поверхностная кожица. Она хорошо заметна на поперечном разрезе многих трутовиков. Другая особенность — довольно толстый слой бесплодной ткани, прикрывающий сверху спороносный слой многочисленных древоразрушителей. Главенствующая роль в сохранении жизнеспособности трутовиков принадлежит мицелию. Грибница всех древоразрушителей хорошо защищена от непогоды корой и тканями дерева. Паразиты (биотрофы) из числа грибов-древоразрушителей вместе с живыми тканями дерева вступают в фазу зимнего покоя, а в первые весенние месяцы мицелий вместе с растением-хозяином "просыпается" и, потребляя его питательные вещества, начинает снабжать ими плодовые тела, возобновляющие активную жизнедеятельность. Подобное явление наблюдается и у грибов-ксилосапротрофов, но мицелий их сохраняет жизнеспособность под покровом уже отмерших древесных тканей.
 Некоторые пластинчатые грибы — чешуйчатки, вешенка легочная, опенок осенний и др. — растут на стволах живых деревьев
Спороносный слой плодовых тел древоразрушающих грибов различного типа:
• трубчатый,
• складчатый,
• гладкий,
• шиповатый,
• бугорчатый и т. д.
Трубчатый спороносный слой, или гименофор, всех многолетних плодовых тел трутовиков ежегодно образует новые слои. Весной прошлогодние трубочки зарастают слоем мицелия, впоследствии уплотняющимся, и формируются новые трубочки. Таким образом, развивается новый слой, начинающий функционировать в начале или середине лета. На поверхности плодовых тел некоторых трутовиков, например настоящего, хорошо заметны зоны, означающие ежегодный прирост гименофора. По ним можно ориентировочно определить возраст плодового тела. Складчатый, лабиринтовидный гименофор у разных видов из родов дедалия и дедалиопсис всегда однослойный.
Некоторые пластинчатые грибы — чешуйчатки, вешенка легочная, опенок осенний и др. — растут на стволах живых деревьев
Спороносный слой плодовых тел древоразрушающих грибов различного типа:
• трубчатый,
• складчатый,
• гладкий,
• шиповатый,
• бугорчатый и т. д.
Трубчатый спороносный слой, или гименофор, всех многолетних плодовых тел трутовиков ежегодно образует новые слои. Весной прошлогодние трубочки зарастают слоем мицелия, впоследствии уплотняющимся, и формируются новые трубочки. Таким образом, развивается новый слой, начинающий функционировать в начале или середине лета. На поверхности плодовых тел некоторых трутовиков, например настоящего, хорошо заметны зоны, означающие ежегодный прирост гименофора. По ним можно ориентировочно определить возраст плодового тела. Складчатый, лабиринтовидный гименофор у разных видов из родов дедалия и дедалиопсис всегда однослойный.
 Некоторые пластинчатые грибы — чешуйчатки, вешенка легочная, опенок осенний и др. — растут на стволах живых деревьев
Форма плодовых тел, на которых располагается спороносный слой, у трутовиков различна. Одни из них распростерты по субстрату в виде слоя переплетенных гиф. Чаще такие распростертые плодовые тела образуются на обращенной к земле поверхности поваленных стволов, обломанных и опавших сучьев и ветвей, и поэтому их трудно заметить. Другие плодовые тела хорошо видны: они имеют форму шляповидных или копытообразных, полукруглых, веерообразных, почковидных, подушковидных или продолговатых образований.
Некоторые пластинчатые грибы — чешуйчатки, вешенка легочная, опенок осенний и др. — растут на стволах живых деревьев
Форма плодовых тел, на которых располагается спороносный слой, у трутовиков различна. Одни из них распростерты по субстрату в виде слоя переплетенных гиф. Чаще такие распростертые плодовые тела образуются на обращенной к земле поверхности поваленных стволов, обломанных и опавших сучьев и ветвей, и поэтому их трудно заметить. Другие плодовые тела хорошо видны: они имеют форму шляповидных или копытообразных, полукруглых, веерообразных, почковидных, подушковидных или продолговатых образований.
 Большинство пластинчатых грибов селится на уже отмершей древисине, завершая ее разрушение
На пораженных деревьях трутовики располагаются одиночно или черепитчатыми группами, к субстрату прикрепляются зачаточной боковой ножкой или боком, непосредственно тканью плодового тела. Некоторые трутовики имеют шляповидные плодовые тела с центральной или эксцентрической ножкой. Например, зимний трутовик имеет ножку, обычно равную по длине диаметру шляпки, но увеличивающуюся в зависимости от глубины залегания субстрата.
Большинство пластинчатых грибов селится на уже отмершей древисине, завершая ее разрушение
На пораженных деревьях трутовики располагаются одиночно или черепитчатыми группами, к субстрату прикрепляются зачаточной боковой ножкой или боком, непосредственно тканью плодового тела. Некоторые трутовики имеют шляповидные плодовые тела с центральной или эксцентрической ножкой. Например, зимний трутовик имеет ножку, обычно равную по длине диаметру шляпки, но увеличивающуюся в зависимости от глубины залегания субстрата.
 Большинство пластинчатых грибов селится на уже отмершей древисине, завершая ее разрушение
У древоразрушителей из числа пластинчатых грибов чаще однолетние плодовые тела с пластинчатым спороносным слоем, расположенным на нижней стороне шляпок, прикрепляющихся к субстрату либо боком, например у вешенки обыкновенной или устричной, либо при помощи центральной или эксцентрической ножки. Спороносный слой трутовиков всегда расположен на нижней поверхности плодового тела, что облегчает распространение спор. Если плодовое тело трутовика начало формироваться на живом или отмершем, но вертикально стоящем дереве, то при изменении положения дерева по отношению к земле (наклоне или падении) плодовое тело также изменяет направление роста в сторону его ориентации спороносным слоем к земле. Поэтому на таких стволах развиваются уродливые по внешнему виду плодовые тела. Но эта уродливость имеет глубокий биологический смысл: плодовое тело продолжает жить, функционировать, рассеивать споры и заражать ими соседние деревья. Макромицеты-древоразрушители — основные возбудители болезней типа гнилей, приводящих к изреживанию древостоя и его гибели.
Большинство пластинчатых грибов селится на уже отмершей древисине, завершая ее разрушение
У древоразрушителей из числа пластинчатых грибов чаще однолетние плодовые тела с пластинчатым спороносным слоем, расположенным на нижней стороне шляпок, прикрепляющихся к субстрату либо боком, например у вешенки обыкновенной или устричной, либо при помощи центральной или эксцентрической ножки. Спороносный слой трутовиков всегда расположен на нижней поверхности плодового тела, что облегчает распространение спор. Если плодовое тело трутовика начало формироваться на живом или отмершем, но вертикально стоящем дереве, то при изменении положения дерева по отношению к земле (наклоне или падении) плодовое тело также изменяет направление роста в сторону его ориентации спороносным слоем к земле. Поэтому на таких стволах развиваются уродливые по внешнему виду плодовые тела. Но эта уродливость имеет глубокий биологический смысл: плодовое тело продолжает жить, функционировать, рассеивать споры и заражать ими соседние деревья. Макромицеты-древоразрушители — основные возбудители болезней типа гнилей, приводящих к изреживанию древостоя и его гибели.
 Распил трехлетнего плодового тела трутовика
Среди макромицетов-древоразрушителей много возбудителей стволовых гнилей. Их различают по приуроченности к хвойным или лиственным породам, но некоторые развиваются и на тех и других породах.
Распил трехлетнего плодового тела трутовика
Среди макромицетов-древоразрушителей много возбудителей стволовых гнилей. Их различают по приуроченности к хвойным или лиственным породам, но некоторые развиваются и на тех и других породах.
 Настоящий трутовик, на котором хорошо видны горичные слои
Среди виновников гнилей хвойных пород наиболее известны сосновая и еловая губки, окаймленный трутовик.
Плодовые тела сосновой и еловой губки легко различимы. У еловой они тонкие, плоские, полураспростертые, иногда черепитчато расположенные и часто образующие тонкую корку, а у сосновой — типично шляпо-, копыто- или козырьковивные. Оба гриба схожи по циклу развития и паразитическим свойствам. Заражение ими деревьев происходит через сучья и глубокие поранения. Грибница, распространяясь по древесине, разрушает ее, в результате чего уменьшается выход деловой древесины.
Крупные деревянистые с яркой оранжево-красной каймой нарастающего края многолетние плодовые тела окаймленного трутовика, часто развивающиеся на валеже и сухостое, знакомы многим любителям леса. С возрастом плодового тела его окраска меняется от желтоватой, киноварно-красной до почти черной. На трубчатом гименофоре образуется масса спор, рассеивающихся по созревании в окружающее пространство и оседающих на стволах, близрастущих лесных растениях, поверхности плодовых тел, отчего они приобретают сероватый оттенок. Наиболее интенсивно споры рассеиваются во влажную погоду. Прорастая, они заражают живые деревья, и гниль быстро распространяется от периферии к центру ствола. Древесина, пораженная грибом, растрескивается в разных направлениях, а в трещинах формируются мицелиальные пленки гриба, разделяющие древесину на мелкие призмы (деструктивная гниль). Кроме живых деревьев, сухостоя, валежа, окаймленный трутовик поражает древесину на складах, в хозяйственных и жилых постройках.
Настоящий трутовик, на котором хорошо видны горичные слои
Среди виновников гнилей хвойных пород наиболее известны сосновая и еловая губки, окаймленный трутовик.
Плодовые тела сосновой и еловой губки легко различимы. У еловой они тонкие, плоские, полураспростертые, иногда черепитчато расположенные и часто образующие тонкую корку, а у сосновой — типично шляпо-, копыто- или козырьковивные. Оба гриба схожи по циклу развития и паразитическим свойствам. Заражение ими деревьев происходит через сучья и глубокие поранения. Грибница, распространяясь по древесине, разрушает ее, в результате чего уменьшается выход деловой древесины.
Крупные деревянистые с яркой оранжево-красной каймой нарастающего края многолетние плодовые тела окаймленного трутовика, часто развивающиеся на валеже и сухостое, знакомы многим любителям леса. С возрастом плодового тела его окраска меняется от желтоватой, киноварно-красной до почти черной. На трубчатом гименофоре образуется масса спор, рассеивающихся по созревании в окружающее пространство и оседающих на стволах, близрастущих лесных растениях, поверхности плодовых тел, отчего они приобретают сероватый оттенок. Наиболее интенсивно споры рассеиваются во влажную погоду. Прорастая, они заражают живые деревья, и гниль быстро распространяется от периферии к центру ствола. Древесина, пораженная грибом, растрескивается в разных направлениях, а в трещинах формируются мицелиальные пленки гриба, разделяющие древесину на мелкие призмы (деструктивная гниль). Кроме живых деревьев, сухостоя, валежа, окаймленный трутовик поражает древесину на складах, в хозяйственных и жилых постройках.
 Трутовик окаймленный
Стволовую гниль многих лиственных пород вызывает ложный трутовик. Его желвакообразные, подушковидные, приплюснуто-плоские, реже копытообразные плодовые тела достигают возраста 40-50 лет. Отличительный признак древесины, зараженной ложным трутовиком, — черные извилистые линии, разделяющие зараженные и здоровые ткани. В конечной стадии гниения в древесине развиваются дупла, часто служащие приютом для птиц-дуплогнездников, например синиц, мухоловок, поползней и т. д. Эти птицы могут быть и разносчиками инфекции в природе. Если ложный трутовик поражает многие лиственные породы, то один из его сородичей — ложный осиновый трутовик заражает только осину. Этот гриб отличается от ложного трутовика полукопытовидными, с расширенным основанием плодовыми телами и продольными, хорошо заметными трещинами на них. Гриб очень плодовит, на одном дереве иногда развивается до 15-20 и более плодовых тел, образующих своеобразную лесенку, уходящую к вершине дерева. Такое дерево обречено на гибель, поскольку мицелий захватывает древесину от основания до кроны, вызывая белую ядровую гниль. При рассматривании древесины больного растения хорошо заметна широкая темно-серая линия, отделяющая здоровую зону от гнилой.
Трутовик окаймленный
Стволовую гниль многих лиственных пород вызывает ложный трутовик. Его желвакообразные, подушковидные, приплюснуто-плоские, реже копытообразные плодовые тела достигают возраста 40-50 лет. Отличительный признак древесины, зараженной ложным трутовиком, — черные извилистые линии, разделяющие зараженные и здоровые ткани. В конечной стадии гниения в древесине развиваются дупла, часто служащие приютом для птиц-дуплогнездников, например синиц, мухоловок, поползней и т. д. Эти птицы могут быть и разносчиками инфекции в природе. Если ложный трутовик поражает многие лиственные породы, то один из его сородичей — ложный осиновый трутовик заражает только осину. Этот гриб отличается от ложного трутовика полукопытовидными, с расширенным основанием плодовыми телами и продольными, хорошо заметными трещинами на них. Гриб очень плодовит, на одном дереве иногда развивается до 15-20 и более плодовых тел, образующих своеобразную лесенку, уходящую к вершине дерева. Такое дерево обречено на гибель, поскольку мицелий захватывает древесину от основания до кроны, вызывая белую ядровую гниль. При рассматривании древесины больного растения хорошо заметна широкая темно-серая линия, отделяющая здоровую зону от гнилой.
 Спороносный слой у ложного осинового трутовика трубчатого, напоминающий коричневую замшу, благодаря мельчайшим порам, незаметным невооруженному глазу
На живых березах, реже рябине и ольхе иногда развиваются из разрывов коры, из мест облома сучьев и других повреждений бесформенные образования в виде неправильных желвакообразных выростов с черной, изрытой глубокими трещинами поверхностью. Эти наросты называют по-разному: чага, рак, цыр и т. д. Обычно чага твердая, трехслойная на разрезе, но в местах истечения березового сока развиваются рыхлые, одноцветные, влажные наросты. Эти наросты бесплодны, а плодовые тела возбудителя чаги, быстро разрушающиеся, появляются под корой около наростов после отмирания дерева в виде распростертых пленок с трубчатым спороносным слоем. Присутствие старых берез, наличие морозобоин, ран, высокая влажность, необходимая для прорастания спор гриба, — таковы условия развития чаги в пределах ареала березы в нашей стране. Сочетание этих факторов и обусловливает распространение чаги в средней и южной тайге, а в горах — в лесном поясе, где есть примесь берез. Гриб вызывает белую стволовую гниль. Чага используется как лекарственное сырье.
Спороносный слой у ложного осинового трутовика трубчатого, напоминающий коричневую замшу, благодаря мельчайшим порам, незаметным невооруженному глазу
На живых березах, реже рябине и ольхе иногда развиваются из разрывов коры, из мест облома сучьев и других повреждений бесформенные образования в виде неправильных желвакообразных выростов с черной, изрытой глубокими трещинами поверхностью. Эти наросты называют по-разному: чага, рак, цыр и т. д. Обычно чага твердая, трехслойная на разрезе, но в местах истечения березового сока развиваются рыхлые, одноцветные, влажные наросты. Эти наросты бесплодны, а плодовые тела возбудителя чаги, быстро разрушающиеся, появляются под корой около наростов после отмирания дерева в виде распростертых пленок с трубчатым спороносным слоем. Присутствие старых берез, наличие морозобоин, ран, высокая влажность, необходимая для прорастания спор гриба, — таковы условия развития чаги в пределах ареала березы в нашей стране. Сочетание этих факторов и обусловливает распространение чаги в средней и южной тайге, а в горах — в лесном поясе, где есть примесь берез. Гриб вызывает белую стволовую гниль. Чага используется как лекарственное сырье.
 Располагаясь на стволе в местах отхождения сучьев, он способствует образованию дупел
Плодовые тела березового трутовика или березовой губки обращают на себя внимание лишь в конце лета. Они округлые или почковидные, покрытые слегка растрескивающейся желтоватой или серо-дымчатой кожицей, прикрепляются к стволу боком или зачаточной ножкой. Плодовые тела березовой губки подвергаются нападению насекомых и их личинок, поэтому весной на пораженных березах заметны шляпки грибов с выеденным трубчатым слоем и изуродованные погрызами насекомых, которые и распространяют гриб, перенося инфекцию с больных деревьев на здоровые. Заражение происходит через механические повреждения, и в древесине развивается деструктивная гниль. На живых деревьях плодовые тела образуются редко, чаще они развиваются на сухостое и валеже. Зараженные сухостойные деревья легко обламываются и падают от сильного ветра или обильного снега.
Располагаясь на стволе в местах отхождения сучьев, он способствует образованию дупел
Плодовые тела березового трутовика или березовой губки обращают на себя внимание лишь в конце лета. Они округлые или почковидные, покрытые слегка растрескивающейся желтоватой или серо-дымчатой кожицей, прикрепляются к стволу боком или зачаточной ножкой. Плодовые тела березовой губки подвергаются нападению насекомых и их личинок, поэтому весной на пораженных березах заметны шляпки грибов с выеденным трубчатым слоем и изуродованные погрызами насекомых, которые и распространяют гриб, перенося инфекцию с больных деревьев на здоровые. Заражение происходит через механические повреждения, и в древесине развивается деструктивная гниль. На живых деревьях плодовые тела образуются редко, чаще они развиваются на сухостое и валеже. Зараженные сухостойные деревья легко обламываются и падают от сильного ветра или обильного снега.
 Наросты чаги на живых березах показывают, что дерево уже сильно поражено трутовиком
В лиственных лесах разных растительных зон и на самых разнообразных лиственных породах обычен настоящий трутовик. Он легко отличим от других трутовиков по копытообразным, с ясно выраженной зональностью, с широким основанием и трубчатым гименофором плодовым телам светло- или темно-серого цвета. Этот гриб известен с давних времен: из его ткани выделывали трут, заменявший спички, употребляли ее и в медицинских целях как заменитель ваты. Этим свойством настоящего трутовика можно пользоваться и теперь в случае травм и при отсутствии под руками другого кровоостанавливающего средства.
На одном пораженном дереве гриб образует большое количество плодовых тел разного возраста, например, на одной отмершей березе в Подмосковье мы их насчитали 35! Размеры их различны: от нескольких до десятков сантиметров. Известны экземпляры до 55 см в диаметре! Любопытно, что споры настоящего трутовика малотребовательны к субстрату и могут прорастать на коре многих древесных пород. Но при прорастании на коре растения-хозяина гифы развиваются лучше и последующий их рост происходит в направлении к открытой древесине, так как заражение осуществляется через раны. Из мест проникновения мицелия в древесину грибница распространяется от заболони к центру и вдоль по стволу, вызывая мраморную гниль ствола. Так ее назвали потому, что на продольных срезах заметны здоровые участки древесины, перемежающиеся с больными в виде беловатых выцветов с темными точками и линиями. В конечной стадии гниения древесина становится ломкой, расщепляющейся по годичным кольцам на пластинки, трухлявой.
Черепитчато расположенные однолетние плодовые тела серно-желтого трутовика заметны в молодом возрасте, привлекая внимание светло-желтой или оранжевой поверхностью, и особенно красивы во влажную погоду — поблескивают выделяющиеся ими капельки жидкости. Развиваются они в нижней части зараженных стволов, реже в средней, до 2 м от земли, а мицелий в стволе обнаруживается на высоте 5-8 м. Гриб вызывает бурую сердцевинную гниль, быстро распространяющуюся и разрушающую древесину, в результате чего образуются большие дупла. Серно-желтый трутовик поражает старые дубы, ивы, лиственницы, реже грушу, вишню, белую акацию, липу, тополь, бук, березу, ясень, гледичию, даже тис и эвкалипт. Молодые плодовые тела съедобны, а их масса достигает 6-8 кг.
Наросты чаги на живых березах показывают, что дерево уже сильно поражено трутовиком
В лиственных лесах разных растительных зон и на самых разнообразных лиственных породах обычен настоящий трутовик. Он легко отличим от других трутовиков по копытообразным, с ясно выраженной зональностью, с широким основанием и трубчатым гименофором плодовым телам светло- или темно-серого цвета. Этот гриб известен с давних времен: из его ткани выделывали трут, заменявший спички, употребляли ее и в медицинских целях как заменитель ваты. Этим свойством настоящего трутовика можно пользоваться и теперь в случае травм и при отсутствии под руками другого кровоостанавливающего средства.
На одном пораженном дереве гриб образует большое количество плодовых тел разного возраста, например, на одной отмершей березе в Подмосковье мы их насчитали 35! Размеры их различны: от нескольких до десятков сантиметров. Известны экземпляры до 55 см в диаметре! Любопытно, что споры настоящего трутовика малотребовательны к субстрату и могут прорастать на коре многих древесных пород. Но при прорастании на коре растения-хозяина гифы развиваются лучше и последующий их рост происходит в направлении к открытой древесине, так как заражение осуществляется через раны. Из мест проникновения мицелия в древесину грибница распространяется от заболони к центру и вдоль по стволу, вызывая мраморную гниль ствола. Так ее назвали потому, что на продольных срезах заметны здоровые участки древесины, перемежающиеся с больными в виде беловатых выцветов с темными точками и линиями. В конечной стадии гниения древесина становится ломкой, расщепляющейся по годичным кольцам на пластинки, трухлявой.
Черепитчато расположенные однолетние плодовые тела серно-желтого трутовика заметны в молодом возрасте, привлекая внимание светло-желтой или оранжевой поверхностью, и особенно красивы во влажную погоду — поблескивают выделяющиеся ими капельки жидкости. Развиваются они в нижней части зараженных стволов, реже в средней, до 2 м от земли, а мицелий в стволе обнаруживается на высоте 5-8 м. Гриб вызывает бурую сердцевинную гниль, быстро распространяющуюся и разрушающую древесину, в результате чего образуются большие дупла. Серно-желтый трутовик поражает старые дубы, ивы, лиственницы, реже грушу, вишню, белую акацию, липу, тополь, бук, березу, ясень, гледичию, даже тис и эвкалипт. Молодые плодовые тела съедобны, а их масса достигает 6-8 кг.
 Трутовик серно-желтый
Дубу и буку сильно вредит дубовая губка, вызывая темно-бурую гниль стволов. Плодовые тела дубовой губки хорошо отличимы от плодовых тел других возбудителей стволовых гнилей по форме спороносного слоя, называемого дедалеевидным или лабиринтовидным. У молодых экземпляров он имеет форму широких удлиненных и толстостенных пор или ходов, а у старых — вид извилистых, нередко соединенных тонкими перемычками пластинок. Пораженная древесина теряет технические качества, так как в конечной стадии гниения распадается на отдельные пластинки.
Трутовик серно-желтый
Дубу и буку сильно вредит дубовая губка, вызывая темно-бурую гниль стволов. Плодовые тела дубовой губки хорошо отличимы от плодовых тел других возбудителей стволовых гнилей по форме спороносного слоя, называемого дедалеевидным или лабиринтовидным. У молодых экземпляров он имеет форму широких удлиненных и толстостенных пор или ходов, а у старых — вид извилистых, нередко соединенных тонкими перемычками пластинок. Пораженная древесина теряет технические качества, так как в конечной стадии гниения распадается на отдельные пластинки.
 Дубовая губка
Процесс отмирания леса, вызываемый микро- и макромицетами, прогрессирует с возрастом насаждения. Длительность этого процесса зависит от многих факторов:
• жизнедеятельности грибов-вредителей леса;
• метеорологических условий, улучшающих состояние лесных насаждений.
Дубовая губка
Процесс отмирания леса, вызываемый микро- и макромицетами, прогрессирует с возрастом насаждения. Длительность этого процесса зависит от многих факторов:
• жизнедеятельности грибов-вредителей леса;
• метеорологических условий, улучшающих состояние лесных насаждений.
 Дубовая губка
Дубовая губка
Грибы — разрушители древесины на складах, в технических и бытовых сооружениях
Мы уже знаем, что грибы, поражая живое дерево, способны развиваться и после его гибели на отмерших или срубленных деревьях, переходя от паразитного питания к сапротрофному. Это возможно благодаря наличию у грибов различных ферментов. Но кроме древоразрушителей, способных поражать живые деревья и продолжать функционировать на мертвых, на поделочной древесине развивается комплекс сапротрофных грибов. Видовой состав их зависит от разных факторов, в том числе: • от условий хранения древесины; • стадии ее разложения; • условий эксплуатации. На деловой древесине поселяются своеобразные экологические группы древо-разрушителей, сменяющие друг друга в процессе деструкции древесины. Дупло в дереве — результат деятельности древоразрушающих грибов
Древесина в настоящее время является универсальным, часто незаменимым материалом, имеющим огромное народнохозяйственное значение. Из нее изготавливают десятки тысяч разнообразныхизделий, и трудно назвать такую отрасль нашего хозяйства, где не использовалась бы древесина. Существует целая отрасль науки — древесиноведение, изучающая физические, химические и механические свойства древесины. И одним из вопросов, рассматриваемых в ней, является изучение стойкости древесины против биологических факторов — грибов, бактерий, насекомых. Грибы в этой группе играют важнейшую роль, определяя в значительной степени механическую прочность древесины. Поэтому важно знать, какие именно грибы и как воздействуют на деловую древесину.
Дупло в дереве — результат деятельности древоразрушающих грибов
Древесина в настоящее время является универсальным, часто незаменимым материалом, имеющим огромное народнохозяйственное значение. Из нее изготавливают десятки тысяч разнообразныхизделий, и трудно назвать такую отрасль нашего хозяйства, где не использовалась бы древесина. Существует целая отрасль науки — древесиноведение, изучающая физические, химические и механические свойства древесины. И одним из вопросов, рассматриваемых в ней, является изучение стойкости древесины против биологических факторов — грибов, бактерий, насекомых. Грибы в этой группе играют важнейшую роль, определяя в значительной степени механическую прочность древесины. Поэтому важно знать, какие именно грибы и как воздействуют на деловую древесину.
 Все эти грибы — кориолусы, стерреумы, пория и многие другие — санитары леса и их основная роль — разрушение древесины
На отмершей древесине в лесу или на деловой древесине на складах при неправильном режиме хранения первыми поселяются плесневые и древоокрашивающие грибы. В некоторых случаях окраска древесины возникает под влиянием жизнедеятельности грибов-паразитов, но чаще это явление связано с деятельностью древоокрашивающих грибов, к которым относятся многие сумчатые и несовершенные. Синеву древесины (она проявляется в появлении пятен синеватых, голубоватых, голубовато-серых, серых и синевато-черных оттенков) вызывают несколько десятков микромицетов, из которых наиболее распространены виды рода цератоцистис. Их плодовые тела можно заметить только при рассматривании пораженных участков древесины в лупу. В цикле развития этих грибов имеются и конидиальные стадии, схожие с таковыми у грибов из родов графиум, цефалоспориум и др.; они также микроскопические.
Все эти грибы — кориолусы, стерреумы, пория и многие другие — санитары леса и их основная роль — разрушение древесины
На отмершей древесине в лесу или на деловой древесине на складах при неправильном режиме хранения первыми поселяются плесневые и древоокрашивающие грибы. В некоторых случаях окраска древесины возникает под влиянием жизнедеятельности грибов-паразитов, но чаще это явление связано с деятельностью древоокрашивающих грибов, к которым относятся многие сумчатые и несовершенные. Синеву древесины (она проявляется в появлении пятен синеватых, голубоватых, голубовато-серых, серых и синевато-черных оттенков) вызывают несколько десятков микромицетов, из которых наиболее распространены виды рода цератоцистис. Их плодовые тела можно заметить только при рассматривании пораженных участков древесины в лупу. В цикле развития этих грибов имеются и конидиальные стадии, схожие с таковыми у грибов из родов графиум, цефалоспориум и др.; они также микроскопические.
 Все эти грибы — кориолусы, стерреумы, пория и многие другие — санитары леса и их основная роль — разрушение древесины
Малиново-розовая окраска древесины возникает в результате развития грибов из рода фузариум, а зеленая — видов рода хлоросплениум.
Кроваво-красную окраску вызывает макромицет пениофора гигантская, образующая на лесоматериалах тонкие пленчатые плодовые тела и шнуры красновато-оранжевого цвета.
Все эти грибы — кориолусы, стерреумы, пория и многие другие — санитары леса и их основная роль — разрушение древесины
Малиново-розовая окраска древесины возникает в результате развития грибов из рода фузариум, а зеленая — видов рода хлоросплениум.
Кроваво-красную окраску вызывает макромицет пениофора гигантская, образующая на лесоматериалах тонкие пленчатые плодовые тела и шнуры красновато-оранжевого цвета.
 Все эти грибы — кориолусы, стерреумы, пория и многие другие — санитары леса и их основная роль — разрушение древесины
В процессе хранения лесоматериалов древоокрашивающие грибы постепенно сменяются грибами другой экологической подгруппы — так называемыми складскими или штабельными. Их развитие обусловлено изменениями, происходящими в древесине:
• обезвоживанием;
• снижением запаса питательных веществ;
• изменением механических и физических свойств и т. д.
Микологи их условно подразделяют на слабых и сильных разрушителей древесины.
Все эти грибы — кориолусы, стерреумы, пория и многие другие — санитары леса и их основная роль — разрушение древесины
В процессе хранения лесоматериалов древоокрашивающие грибы постепенно сменяются грибами другой экологической подгруппы — так называемыми складскими или штабельными. Их развитие обусловлено изменениями, происходящими в древесине:
• обезвоживанием;
• снижением запаса питательных веществ;
• изменением механических и физических свойств и т. д.
Микологи их условно подразделяют на слабых и сильных разрушителей древесины.
 Все эти грибы — кориолусы, стерреумы, пория и многие другие — санитары леса и их основная роль — разрушение древесины
К первым относят пениофору гигантскую и щелелистник обыкновенный. По внешнему виду они различны. Пениофора гигантская образует длинные (до 50 см) пленчатые молочно-белые или серовато-кремовые плодовые тела с гладким спороносным слоем. Они воскообразной консистенции, поэтому во влажной атмосфере разбухают, а в сухой съеживаются. У щелелистника маленькие шляпки с веерообразными пластинками. Это не типичные пластинки, которые имеются у пластинчатых грибов, а складки.
Все эти грибы — кориолусы, стерреумы, пория и многие другие — санитары леса и их основная роль — разрушение древесины
К первым относят пениофору гигантскую и щелелистник обыкновенный. По внешнему виду они различны. Пениофора гигантская образует длинные (до 50 см) пленчатые молочно-белые или серовато-кремовые плодовые тела с гладким спороносным слоем. Они воскообразной консистенции, поэтому во влажной атмосфере разбухают, а в сухой съеживаются. У щелелистника маленькие шляпки с веерообразными пластинками. Это не типичные пластинки, которые имеются у пластинчатых грибов, а складки.
 Все эти грибы — кориолусы, стерреумы, пория и многие другие — санитары леса и их основная роль — разрушение древесины
При влажной погоде складочки раздвигаются и споры, освобождаясь, разлетаются, а при сухой края складочек сдвигаются, прикрывая спороносный слой от высыхания.
Это и послужило поводом для названия гриба.
Щелелистник может развиваться и в природных условиях, но всегда на отмершей древесине, а на деловой древесине плодовые тела обычно образуются в щелях, что также оправдывает его название.
Заборный и шпальный грибы названы так по субстратам, на которых чаще всего поселяются. Однако кроме шпал и заборов они разрушают конструкции различных деревянных сооружений и построек (мостов, сараев, погребов, креплений в подземных сооружениях и т. д.). Деревянные конструкции им помогают разрушать и некоторые почвенные микромицеты, если сооружения соприкасаются с почвой и плохо защищены от проникновения в них грибницы. Заборный гриб, или галофиллум заборный, образует тонкие пробковидно-кожистые шляпки с пластинками. Поверхность шляпок гриба темно-коричневая, у основания бугристая, грубовотюкнистая, с концентрическими зонами.
К субстрату грибы прикрепляются боком или полураспростерты на нем. Развиваясь на древесине без доступа света, например на креплениях в шахтах, гриб образует уродливые, неплодоносящие, часто коралловидно ветвящиеся зачатки плодовых тел.
Шпальный гриб, или пилолистник чешуйчатый, в отличие от заборного имеет плотную центральную или эксцентрическую ножку и плотные твердеющие шляпки с низбегающими пластинками, шляпки и ножки покрыты бурыми или коричневыми чешуйками. Пластинки, нисходящие на ножку, с зазубренным краем, что отражено в. другом названии этого гриба — пилолистник чешуйчатый. Гриб поражает не только обработанную древесину хвойных пород, но развивается на пнях и валеже.
В июне — сентябре его плодовые тела можно заметить у основания телеграфных столбов, на стенках погребов и колодцев. В молодом возрате он съедобен, правда, мякоть жестковата.
Вместе с зараженным строительным материалом складские грибы могут попасть в бытовые и производственные помещения с постоянным температурным режимом, однако в этих условиях развиваются они медленно и не имеют большого значения в качестве деструкторов деревянных конструкций.
Все эти грибы — кориолусы, стерреумы, пория и многие другие — санитары леса и их основная роль — разрушение древесины
При влажной погоде складочки раздвигаются и споры, освобождаясь, разлетаются, а при сухой края складочек сдвигаются, прикрывая спороносный слой от высыхания.
Это и послужило поводом для названия гриба.
Щелелистник может развиваться и в природных условиях, но всегда на отмершей древесине, а на деловой древесине плодовые тела обычно образуются в щелях, что также оправдывает его название.
Заборный и шпальный грибы названы так по субстратам, на которых чаще всего поселяются. Однако кроме шпал и заборов они разрушают конструкции различных деревянных сооружений и построек (мостов, сараев, погребов, креплений в подземных сооружениях и т. д.). Деревянные конструкции им помогают разрушать и некоторые почвенные микромицеты, если сооружения соприкасаются с почвой и плохо защищены от проникновения в них грибницы. Заборный гриб, или галофиллум заборный, образует тонкие пробковидно-кожистые шляпки с пластинками. Поверхность шляпок гриба темно-коричневая, у основания бугристая, грубовотюкнистая, с концентрическими зонами.
К субстрату грибы прикрепляются боком или полураспростерты на нем. Развиваясь на древесине без доступа света, например на креплениях в шахтах, гриб образует уродливые, неплодоносящие, часто коралловидно ветвящиеся зачатки плодовых тел.
Шпальный гриб, или пилолистник чешуйчатый, в отличие от заборного имеет плотную центральную или эксцентрическую ножку и плотные твердеющие шляпки с низбегающими пластинками, шляпки и ножки покрыты бурыми или коричневыми чешуйками. Пластинки, нисходящие на ножку, с зазубренным краем, что отражено в. другом названии этого гриба — пилолистник чешуйчатый. Гриб поражает не только обработанную древесину хвойных пород, но развивается на пнях и валеже.
В июне — сентябре его плодовые тела можно заметить у основания телеграфных столбов, на стенках погребов и колодцев. В молодом возрате он съедобен, правда, мякоть жестковата.
Вместе с зараженным строительным материалом складские грибы могут попасть в бытовые и производственные помещения с постоянным температурным режимом, однако в этих условиях развиваются они медленно и не имеют большого значения в качестве деструкторов деревянных конструкций.
 Приуроченность некоторых древоразрушающих грибов к субстрату и их биологическим свойствам
В отапливаемых помещениях наибольшую опасность представляет своеобразная группа грибов-ксилотрофов, включающая домовые грибы: настоящий, белый, пленчатый и пластинчатый, или шахтный. Они способны развиваться в широких пределах температуры: от 5 до 37°С с оптимумом 20-27°С (настоящий домовый гриб выдерживает температуру до 37°С). Эти грибы одинаково требовательны к относительной влажности воздуха (наиболее благоприятна влажность 80-85%), но по-разному реагируют на влажность древесины. Для развития настоящего домового гриба достаточна влажность древесины 19-22%, для пленчатого 34-46 и для белого и пластинчатого 50-70%. Гифы их способны длительное время сохраняться в древесине при влажности 11%. Грибы предпочитают кислую реакцию среды и лучше развиваются при значениях рН 3-6.
Домовые грибы развиваются в зданиях при использовании в строительстве непросушенных материалов или при неправильной эксплуатации зданий. Заражение древесины происходит спорами или обрывками мицелия. Грибница распространяется по древесине, образуя плодовые тела, специфичные для каждого гриба.
Приуроченность некоторых древоразрушающих грибов к субстрату и их биологическим свойствам
В отапливаемых помещениях наибольшую опасность представляет своеобразная группа грибов-ксилотрофов, включающая домовые грибы: настоящий, белый, пленчатый и пластинчатый, или шахтный. Они способны развиваться в широких пределах температуры: от 5 до 37°С с оптимумом 20-27°С (настоящий домовый гриб выдерживает температуру до 37°С). Эти грибы одинаково требовательны к относительной влажности воздуха (наиболее благоприятна влажность 80-85%), но по-разному реагируют на влажность древесины. Для развития настоящего домового гриба достаточна влажность древесины 19-22%, для пленчатого 34-46 и для белого и пластинчатого 50-70%. Гифы их способны длительное время сохраняться в древесине при влажности 11%. Грибы предпочитают кислую реакцию среды и лучше развиваются при значениях рН 3-6.
Домовые грибы развиваются в зданиях при использовании в строительстве непросушенных материалов или при неправильной эксплуатации зданий. Заражение древесины происходит спорами или обрывками мицелия. Грибница распространяется по древесине, образуя плодовые тела, специфичные для каждого гриба.
 Настоящий домовый гриб
У настоящего домового гриба плодовые тела широкораспростертые, иногда очень большие, до 0,5 м в диаметре, со складчатым, ячеистым спороносным слоем вначале охряно-желтым, затем от ярко-ржавого до ржаво-коричневого. Он характеризуется высокой плодовитостью — за сутки может выделить до 1 млн. спор, а во время споруляции в 1 мЗ воздуха их обнаруживается до 80 тыс. Распространение гриба по поверхности стен, а также с одного этажа на другой происходит при помощи толстых мицелиальных шнуров. Для них доказана возможность роста на известково-песчаной штукатурке с влажностью около 1%, на кирпичной и каменной кладке фундамента и стен. Все эти субстраты могут служить местом сохранения инфекции.
У белого домового гриба редко бывают плодовые тела, а в бесплодной стадии он существует в виде обильного белого хлопьевидного мицелия, часто образующего толстые мицелиальные шнуры и пленки, лучистые или веерообразные. В отличие от него пленчатый домовый гриб характеризуется слаборазвитым желтоватым мицелием, образующим веерообразно ветвящиеся тяжи коричневого, почти черного цвета.
Резко отличается от вышеописанных домовых грибов пластинчатый домовый, или шахтный, гриб, образующий бесцветный паутинистый мицелий, иногда с фиолетовым или лиловатым оттенком. Плодовые тела имеют вид шляпок без ножек или с зачаточной ножкой. Цвет шляпки желто-охряный, иногда с фиолетовым оттенком, на ее нижней поверхности радиально расходящиеся дихотомически ветвящиеся пластинки. Гриб образует также мицелиальные шнуры, но тонкие, нитевидные, разветвленные, сначала светлые, а потом зеленовато-желтые.
Настоящий домовый гриб
У настоящего домового гриба плодовые тела широкораспростертые, иногда очень большие, до 0,5 м в диаметре, со складчатым, ячеистым спороносным слоем вначале охряно-желтым, затем от ярко-ржавого до ржаво-коричневого. Он характеризуется высокой плодовитостью — за сутки может выделить до 1 млн. спор, а во время споруляции в 1 мЗ воздуха их обнаруживается до 80 тыс. Распространение гриба по поверхности стен, а также с одного этажа на другой происходит при помощи толстых мицелиальных шнуров. Для них доказана возможность роста на известково-песчаной штукатурке с влажностью около 1%, на кирпичной и каменной кладке фундамента и стен. Все эти субстраты могут служить местом сохранения инфекции.
У белого домового гриба редко бывают плодовые тела, а в бесплодной стадии он существует в виде обильного белого хлопьевидного мицелия, часто образующего толстые мицелиальные шнуры и пленки, лучистые или веерообразные. В отличие от него пленчатый домовый гриб характеризуется слаборазвитым желтоватым мицелием, образующим веерообразно ветвящиеся тяжи коричневого, почти черного цвета.
Резко отличается от вышеописанных домовых грибов пластинчатый домовый, или шахтный, гриб, образующий бесцветный паутинистый мицелий, иногда с фиолетовым или лиловатым оттенком. Плодовые тела имеют вид шляпок без ножек или с зачаточной ножкой. Цвет шляпки желто-охряный, иногда с фиолетовым оттенком, на ее нижней поверхности радиально расходящиеся дихотомически ветвящиеся пластинки. Гриб образует также мицелиальные шнуры, но тонкие, нитевидные, разветвленные, сначала светлые, а потом зеленовато-желтые.
 Пленчатый домовый гриб: а — разрушенная древесина; б — шнуровидный мицелий; в — плодовое тело гриба на доске
Несмотря на то, что все домовые грибы развиваются на древесине и в сравнительно схожих условиях, у них имеется некоторая приуроченность, хотя и не обязательная, к древесине разных пород. Так, настоящий домовый гриб предпочитает древесину мягколиственных и хвойных пород, а белый домовый — только хвойных, пленчатый домовый разрушает древесину не только хвойных, но и лиственных, кроме дуба и белой акации, пластинчатый разлагает сосновую древесину, используемую в погребах с торфяной засыпкой и в шахтах.
Таким образом, многие виды микро- и макромицетов вредят лесу и древесине, однако многие грибы-сапротрофы осуществляют разложение отмерших деревьев, порубочных остатков, тем самым очищая лес.
Пленчатый домовый гриб: а — разрушенная древесина; б — шнуровидный мицелий; в — плодовое тело гриба на доске
Несмотря на то, что все домовые грибы развиваются на древесине и в сравнительно схожих условиях, у них имеется некоторая приуроченность, хотя и не обязательная, к древесине разных пород. Так, настоящий домовый гриб предпочитает древесину мягколиственных и хвойных пород, а белый домовый — только хвойных, пленчатый домовый разрушает древесину не только хвойных, но и лиственных, кроме дуба и белой акации, пластинчатый разлагает сосновую древесину, используемую в погребах с торфяной засыпкой и в шахтах.
Таким образом, многие виды микро- и макромицетов вредят лесу и древесине, однако многие грибы-сапротрофы осуществляют разложение отмерших деревьев, порубочных остатков, тем самым очищая лес.
Грибы — санитары леса
Грибам принадлежит первенствующая роль в разрушении лесного опада и, как следствие этого процесса, в круговороте веществ в природе. Это они очищают почву от многочисленных опавших листьев, хвои, веточек. Это грибы вместе с представителями других групп живых организмов, роль которых в этом процессе, однако, невелика, разрушают пни деревьев, сухостой, сломанные и поваленные ветром стволы, колоды, оставшиеся в лесу на месте рубок. Множество микро- и макромицетов из числа сапротрофов поселяются на хвойном и листовом опаде, пнях, отмерших стволах, разлагают их, очищая поверхность почвы и подготавливая почву для заселения новыми поколениями растений. Многие, видимо, гуляя по лесу, обращали внимание на поваленные бурей стволы, заросшие мхами, лишайниками, травами. Они кажутся сказочными крепкими великанами, но попробуйте влезть на такой ствол — и под тяжестью тела образуется глубокая яма или трещина и нога провалится глубоко внутрь... Это уже не ствол-богатырь, а трухлявая древесина. Процесс разрушения древесины длителен, и его скорость зависит от количества лесного опада и условий, в которых он происходит, от активности древоразрушителей. Наиболее быстро минерализации подвергаются опавшие листья и хвоя. Богатые легкодоступными органическими соединениями, они разрушаются грибами быстрее, чем более крупные ветки, покрытые корой. На ветвях продолжают развитие грибы, жизненный цикл которых проходит в двух фазах: • паразитной • сапротрофной. Весной на хвое и листьях, еще не перегнивших и составляющих верхний слой подстилки, через который пробиваются светло-зеленые стрелки молодых растений, заметны невооруженным глазом множество черных точек и бархатистые налеты темного цвета. Это спороношения и плодоношения микромицетов (например, ритисмы, лофодермиума и др.), продолжающих сапротрофно развиваться на опавших листьях и хвое, и специфических сапротрофов — разрушителей лесного опада. Среди опавшей листвы можно найти листья с разрушенной тканью и оставшимися неразрушенными жилками (склеротизированные листья) — тоже результат деятельности сапротрофов и факультативных сапротрофов. К разрушителям опада присоединяются грибы, обитающие в подстилке. Эта экологическая группа грибов неоднородна, и ведущее место в ней занимают микромицеты почвы, подстилки и макромицеты — подстилочные сапротрофы. Те, кто бродил в лесу, не раз обращал внимание на поваленные стволы, заросшие мхами, лишайниками, грибами. Эта трухлявая древесина — все, что осталось от красавицы ели, великана дуба или белоствольной березы
Разложение лесного опада (мелких веточек, крупных сучьев, колод, мертвых стволов) также осуществляют сначала грибы, жизненный цикл которых начинается с паразитической фазы, а заканчивается сапротрофной. Это уже известные нам трутовики. О том, что мицелий этих паразитов продолжает свою разрушительную деятельность, можно судить по присутствию спороносящих плодовых тел на отмершей древесине, на пнях. Но не весь лесной опад бывает поражен древоразрушителями-паразитами, и тогда мертвая древесина заселяется древоокрашивающими грибами, осуществляющими первый этап разрушения древесины. Эти грибы не нарушают механической прочности древесины, но изменяют ее химический состав. Начиная процесс разложения, они подготавливают древесину для заселения другими, основными разрушителями древесины. На ветвях с корой поселяются грибы — кортикальные сапротрофы, разрушающие кору. Среди них — трутовики-паразиты, поражающие живые деревья и продолжающие разрушать мертвую древесину, и трутовики-сапротрофы, проникающие в уже отмершие кору и древесные ткани. Это они осуществляют вторую фазу разложения, во время которой древесина теряет свои механические свойства и в зависимости от ферментативной активности древоразрушителей либо распадается на отдельные пластины, либо крошится, превращаясь при растирании в порошок. На частично разложившейся древесине ели и сосны в лесах северотаежной зоны развиваются плодовые тела окаймленного трутовика и корневой губки. Их и других древоразрушителей сопровождают сопутствующие грибы — микро- и макромицеты, потребляющие продукты расщепления сложных соединений древесины и продукты метаболизма грибов.
Те, кто бродил в лесу, не раз обращал внимание на поваленные стволы, заросшие мхами, лишайниками, грибами. Эта трухлявая древесина — все, что осталось от красавицы ели, великана дуба или белоствольной березы
Разложение лесного опада (мелких веточек, крупных сучьев, колод, мертвых стволов) также осуществляют сначала грибы, жизненный цикл которых начинается с паразитической фазы, а заканчивается сапротрофной. Это уже известные нам трутовики. О том, что мицелий этих паразитов продолжает свою разрушительную деятельность, можно судить по присутствию спороносящих плодовых тел на отмершей древесине, на пнях. Но не весь лесной опад бывает поражен древоразрушителями-паразитами, и тогда мертвая древесина заселяется древоокрашивающими грибами, осуществляющими первый этап разрушения древесины. Эти грибы не нарушают механической прочности древесины, но изменяют ее химический состав. Начиная процесс разложения, они подготавливают древесину для заселения другими, основными разрушителями древесины. На ветвях с корой поселяются грибы — кортикальные сапротрофы, разрушающие кору. Среди них — трутовики-паразиты, поражающие живые деревья и продолжающие разрушать мертвую древесину, и трутовики-сапротрофы, проникающие в уже отмершие кору и древесные ткани. Это они осуществляют вторую фазу разложения, во время которой древесина теряет свои механические свойства и в зависимости от ферментативной активности древоразрушителей либо распадается на отдельные пластины, либо крошится, превращаясь при растирании в порошок. На частично разложившейся древесине ели и сосны в лесах северотаежной зоны развиваются плодовые тела окаймленного трутовика и корневой губки. Их и других древоразрушителей сопровождают сопутствующие грибы — микро- и макромицеты, потребляющие продукты расщепления сложных соединений древесины и продукты метаболизма грибов.
 Все эти грибы активно включаются в процесс разрушения древесины
Распад отмершей древесины березы в значительной степени осуществляется настоящим, плоским и березовым трутовиками. Они же часто разрушают древесину и других лиственных пород. Кроме этих трутовиков, полуразложившуюся древесину разлагают различные виды кориолусов, чьи тонкие, перепончатые плодовые тела часто в огромных количествах покрывают отмершие стволы. Кориолус многоцветный при росте на торцах пней развивает красивые многоцветные розетки плодовых тел, поверхность которых опушена, отчего на ощупь они бархатистые. На вертикально расположенных или лежащих колодах кориолусы многоцветный и зональный образуют черепитчато растущие, сросшиеся основанием группы плодовых тел. Эти два гриба различаются по опушению и окраске шляпки. В окраске кориолуса зонального преобладают сероватые, буро-охряные и ржаво-кремовые тона, а на шляпке многоцветного чередуются разноцветные зоны с оттенками желтого, красноватого, бурого, серого и черного цветов. Оба гриба — активные разрушители древесины и встречаются в разных климатических зонах.
Все эти грибы активно включаются в процесс разрушения древесины
Распад отмершей древесины березы в значительной степени осуществляется настоящим, плоским и березовым трутовиками. Они же часто разрушают древесину и других лиственных пород. Кроме этих трутовиков, полуразложившуюся древесину разлагают различные виды кориолусов, чьи тонкие, перепончатые плодовые тела часто в огромных количествах покрывают отмершие стволы. Кориолус многоцветный при росте на торцах пней развивает красивые многоцветные розетки плодовых тел, поверхность которых опушена, отчего на ощупь они бархатистые. На вертикально расположенных или лежащих колодах кориолусы многоцветный и зональный образуют черепитчато растущие, сросшиеся основанием группы плодовых тел. Эти два гриба различаются по опушению и окраске шляпки. В окраске кориолуса зонального преобладают сероватые, буро-охряные и ржаво-кремовые тона, а на шляпке многоцветного чередуются разноцветные зоны с оттенками желтого, красноватого, бурого, серого и черного цветов. Оба гриба — активные разрушители древесины и встречаются в разных климатических зонах.
 Все эти грибы активно включаются в процесс разрушения древесины
На полуразложившейся древесине поселяются и виды рода гиршиопорус, привлекающие взор фиолетовым оттенком спороносного слоя. Гиршиопорус еловый обычен на древесине хвойных, а гиршиопорус пергаментный — на древесине лиственных пород. При рассматривании в лупу спороносного слоя гиршиопорусов на нем видны зубчато-рассеченные трубочки; трубочки и фиолетовый оттенок спороносного слоя отличают грибы этого рода от других поселяющихся на полуразложившейся древесине трутовиков — видов стереум и бьеркандера. Грибы рода бьеркандера можно отличить от других родов по темной полосе на границе стерильной ткани шляпки и спороносного слоя, которая хорошо заметна при рассматривании в лупу.
Все эти грибы активно включаются в процесс разрушения древесины
На полуразложившейся древесине поселяются и виды рода гиршиопорус, привлекающие взор фиолетовым оттенком спороносного слоя. Гиршиопорус еловый обычен на древесине хвойных, а гиршиопорус пергаментный — на древесине лиственных пород. При рассматривании в лупу спороносного слоя гиршиопорусов на нем видны зубчато-рассеченные трубочки; трубочки и фиолетовый оттенок спороносного слоя отличают грибы этого рода от других поселяющихся на полуразложившейся древесине трутовиков — видов стереум и бьеркандера. Грибы рода бьеркандера можно отличить от других родов по темной полосе на границе стерильной ткани шляпки и спороносного слоя, которая хорошо заметна при рассматривании в лупу.
 Все эти грибы активно включаются в процесс разрушения древесины
Процесс распада древесины лесных пород в естественных условиях осуществляют грибы многих видов.
Все эти грибы активно включаются в процесс разрушения древесины
Процесс распада древесины лесных пород в естественных условиях осуществляют грибы многих видов.
 Все эти грибы активно включаются в процесс разрушения древесины
В разложении древесины хвойных пород преобладают грибы из родов стереум, фомитопсис, глеофиллум, кориоллелус, кортициум, гиршиопорус и др. На древесине лиственных пород широко представлены виды родов кориоллелус, кориолус, гиршиопорус, фомес, пиптопорус, кортициум, мерулиус, церрена и др. Некоторые виды перечисленных родов разрушают древесину и хвойных и лиственных пород. Каждый вид древоразрушителя при развитии на древесине выполняет определенную функцию в разложении субстрата. Функциональные особенности того или иного вида можно выяснить только в условиях эксперимента, ибо в природе трудно проследить распространение мицелия разных древоразрушителей в колодах, пнях, отмерших ветвях, поскольку морфологически мицелий всех базидиальных грибов сходен. Наблюдения показывают, что участки отмершей древесины, захваченные мицелием одного какого-либо деструктора, не заселяются другими видами, осуществляющими эту же фазу распада древесины. Вероятно, и в этих условиях победа остается за мицелием того гриба, который физиологически активно противоборствует появлению конкурирующих форм. Антагонизм одного гриба по отношению к другому в этих случаях зависит от вооруженности гриба ферментами,. способными разрушать специфические вещества древесных пород (например, смолу хвойных, дубильных веществ некоторых лиственных и т. д.).
Все эти грибы активно включаются в процесс разрушения древесины
В разложении древесины хвойных пород преобладают грибы из родов стереум, фомитопсис, глеофиллум, кориоллелус, кортициум, гиршиопорус и др. На древесине лиственных пород широко представлены виды родов кориоллелус, кориолус, гиршиопорус, фомес, пиптопорус, кортициум, мерулиус, церрена и др. Некоторые виды перечисленных родов разрушают древесину и хвойных и лиственных пород. Каждый вид древоразрушителя при развитии на древесине выполняет определенную функцию в разложении субстрата. Функциональные особенности того или иного вида можно выяснить только в условиях эксперимента, ибо в природе трудно проследить распространение мицелия разных древоразрушителей в колодах, пнях, отмерших ветвях, поскольку морфологически мицелий всех базидиальных грибов сходен. Наблюдения показывают, что участки отмершей древесины, захваченные мицелием одного какого-либо деструктора, не заселяются другими видами, осуществляющими эту же фазу распада древесины. Вероятно, и в этих условиях победа остается за мицелием того гриба, который физиологически активно противоборствует появлению конкурирующих форм. Антагонизм одного гриба по отношению к другому в этих случаях зависит от вооруженности гриба ферментами,. способными разрушать специфические вещества древесных пород (например, смолу хвойных, дубильных веществ некоторых лиственных и т. д.).
 Все эти грибы активно включаются в процесс разрушения древесины
Полуразложившаяся древесина — еще и основное место обитания грибов-дрожалок. Их студенистые по-разному окрашенные плодовые тела (светлые, яркие, желтовато-оранжевые или темные коричневые, бурые, черные) особенно заметны во влажную погоду, а в сухую подсыхают, превращаясь в плоские малозаметные корочки, не теряющие, однако, жизнеспособности. После дождя они восстанавливают свойственную им консистенцию и форму. Форма дрожалок причудлива. Это и уховидные аурикулярии, и подушковидные мозговидно-складчатые эксидии, и лопатообразные прямостоячие тремикусы, и роговидные, кустисторазветвленные калоцеры.
Все эти грибы активно включаются в процесс разрушения древесины
Полуразложившаяся древесина — еще и основное место обитания грибов-дрожалок. Их студенистые по-разному окрашенные плодовые тела (светлые, яркие, желтовато-оранжевые или темные коричневые, бурые, черные) особенно заметны во влажную погоду, а в сухую подсыхают, превращаясь в плоские малозаметные корочки, не теряющие, однако, жизнеспособности. После дождя они восстанавливают свойственную им консистенцию и форму. Форма дрожалок причудлива. Это и уховидные аурикулярии, и подушковидные мозговидно-складчатые эксидии, и лопатообразные прямостоячие тремикусы, и роговидные, кустисторазветвленные калоцеры.
 Дрожалковые и гнездовые грибы продолжают разрушение древесины, начатое трутовиками. Гнездовковые грибы относятся к группе дождевиковых, но редко привлекают к себе внимание из-за малых размеров, хотя оригинальность формы, напоминающей птичьи гнезда, они значительно превосходят многие грибы
Все они сапротрофы и продолжают разрушение древесины, начатое трутовиками.
Дрожалковые и гнездовые грибы продолжают разрушение древесины, начатое трутовиками. Гнездовковые грибы относятся к группе дождевиковых, но редко привлекают к себе внимание из-за малых размеров, хотя оригинальность формы, напоминающей птичьи гнезда, они значительно превосходят многие грибы
Все они сапротрофы и продолжают разрушение древесины, начатое трутовиками.
 Дрожалковые и гнездовые грибы продолжают разрушение древесины, начатое трутовиками. Гнездовковые грибы относятся к группе дождевиковых, но редко привлекают к себе внимание из-за малых размеров, хотя оригинальность формы, напоминающей птичьи гнезда, они значительно превосходят многие грибы
На гниющей древесине поселяются и многочисленные гнездовки, плодовые тела которых в виде маленьких птичьих гнездышек заметны на отмершей древесине. Несозревшие плодовые тела их имеют форму некрупных бокалов, кубков, сверху покрытых тонкой пленкой. При созревании пленка разрывается и на дне бокальчика обнаруживаются округлые тельца (перидиоли), служащие для размножения гриба. Мицелий гнездовок пронизывает гнилушки разных древесно-кустарниковых пород. Вслед за ними или одновременно с ними на почти полностью разрушенных колодах, пнях, ветвях появляются различные мелкие макромицеты — шляпочные грибы из порядка агариковых (пластинчатых), иногда покрывающих остатки древесного отпада сплошной массой. Это различные мицены, гифоломы, ксеромфалины, псатиреллы и др. Они осуществляют последнюю фазу разрушения древесины (фазу гумификации), в результате чего древесина становится еще более рыхлой, постепенно покрывается мхами и зелеными растениями. И вот уже ничто не напоминает о том, что на этом месте лежало поваленное дерево или куча ветвей, коры или стоял пень. Но, оказывается, древесина не исчезла, а лишь претерпела под действием грибов длительный процесс превращения — это они своими ферментами расконсервировали законсервированные в высокомолекулярных соединениях мертвой древесины огромные количества вещества и энергии, которые на протяжении всей жизни синтезировали живые деревья. Если бы не было грибов — санитаров леса, эти запасы не могли бы включиться в круговорот вещества в природе, вследствие чего не восстанавливалось бы количество углекислого газа в атмосфере и, как следствие этого, прекратились бы фотосинтез и выделение кислорода. Но этого не происходит, так как в процессе разложения древесины осуществляются последовательные и взаимосвязанные реакции освобождения различных соединений. Каждый этап сопровождается сменой различных групп гетеротрофных организмов и в первую очередь грибов. На разных этапах разложения грибами органических веществ древесины промежуточные и конечные соединения этого процесса включаются в круговорот веществ.
Дрожалковые и гнездовые грибы продолжают разрушение древесины, начатое трутовиками. Гнездовковые грибы относятся к группе дождевиковых, но редко привлекают к себе внимание из-за малых размеров, хотя оригинальность формы, напоминающей птичьи гнезда, они значительно превосходят многие грибы
На гниющей древесине поселяются и многочисленные гнездовки, плодовые тела которых в виде маленьких птичьих гнездышек заметны на отмершей древесине. Несозревшие плодовые тела их имеют форму некрупных бокалов, кубков, сверху покрытых тонкой пленкой. При созревании пленка разрывается и на дне бокальчика обнаруживаются округлые тельца (перидиоли), служащие для размножения гриба. Мицелий гнездовок пронизывает гнилушки разных древесно-кустарниковых пород. Вслед за ними или одновременно с ними на почти полностью разрушенных колодах, пнях, ветвях появляются различные мелкие макромицеты — шляпочные грибы из порядка агариковых (пластинчатых), иногда покрывающих остатки древесного отпада сплошной массой. Это различные мицены, гифоломы, ксеромфалины, псатиреллы и др. Они осуществляют последнюю фазу разрушения древесины (фазу гумификации), в результате чего древесина становится еще более рыхлой, постепенно покрывается мхами и зелеными растениями. И вот уже ничто не напоминает о том, что на этом месте лежало поваленное дерево или куча ветвей, коры или стоял пень. Но, оказывается, древесина не исчезла, а лишь претерпела под действием грибов длительный процесс превращения — это они своими ферментами расконсервировали законсервированные в высокомолекулярных соединениях мертвой древесины огромные количества вещества и энергии, которые на протяжении всей жизни синтезировали живые деревья. Если бы не было грибов — санитаров леса, эти запасы не могли бы включиться в круговорот вещества в природе, вследствие чего не восстанавливалось бы количество углекислого газа в атмосфере и, как следствие этого, прекратились бы фотосинтез и выделение кислорода. Но этого не происходит, так как в процессе разложения древесины осуществляются последовательные и взаимосвязанные реакции освобождения различных соединений. Каждый этап сопровождается сменой различных групп гетеротрофных организмов и в первую очередь грибов. На разных этапах разложения грибами органических веществ древесины промежуточные и конечные соединения этого процесса включаются в круговорот веществ.
 Дрожалковые и гнездовые грибы продолжают разрушение древесины, начатое трутовиками. Все эти грибы вктивно включаются в процесс разрушения древесины. Гнездовковые грибы относятся к группе дождевиковых, но редко привлекают к себе внимание из-за малых размеров, хотя оригинальность формы, напоминающей птичьи гнезда, они значительно превосходят многие грибы
Грибы быстро разрушают простые сахара и полисахариды до углекислого газа и воды. Грибам принадлежит важная роль в превращении органических соединений, содержащих азот, фосфор, серу и другие минеральные элементы. В дальнейшем биомасса самих древоразрушителей подвергается разрушению другими гетеротрофами. Ими могут быть грибы, паразитирующие на грибах (микопаразиты) или сапротрофы, бактерии, многочисленные беспозвоночные животные (личинки комаров, мух, жуков-грибоедов, чернотелок, щелкунов, гусеницы бабочек и др.). Воздействие их особенно заметно на уже отмерших плодовых телах древоразрушающих грибов, где видны ходы насекомых, погрызы и т. п.. Эти организмы осуществляют дальнейшую минерализацию биомассы грибов, разлагая ее до более простых соединений.
Все это свидетельствует о разноплановой деятельности древоразрушающих грибов в природе. В этом проявляется диалектическое единство процессов, происходящих в ней.
Дрожалковые и гнездовые грибы продолжают разрушение древесины, начатое трутовиками. Все эти грибы вктивно включаются в процесс разрушения древесины. Гнездовковые грибы относятся к группе дождевиковых, но редко привлекают к себе внимание из-за малых размеров, хотя оригинальность формы, напоминающей птичьи гнезда, они значительно превосходят многие грибы
Грибы быстро разрушают простые сахара и полисахариды до углекислого газа и воды. Грибам принадлежит важная роль в превращении органических соединений, содержащих азот, фосфор, серу и другие минеральные элементы. В дальнейшем биомасса самих древоразрушителей подвергается разрушению другими гетеротрофами. Ими могут быть грибы, паразитирующие на грибах (микопаразиты) или сапротрофы, бактерии, многочисленные беспозвоночные животные (личинки комаров, мух, жуков-грибоедов, чернотелок, щелкунов, гусеницы бабочек и др.). Воздействие их особенно заметно на уже отмерших плодовых телах древоразрушающих грибов, где видны ходы насекомых, погрызы и т. п.. Эти организмы осуществляют дальнейшую минерализацию биомассы грибов, разлагая ее до более простых соединений.
Все это свидетельствует о разноплановой деятельности древоразрушающих грибов в природе. В этом проявляется диалектическое единство процессов, происходящих в ней.
Как защитить лес от болезней
Лес, страдающий от множества видимых и невидимых врагов, требует защиты. И на помощь ему приходят работники лесного хозяйства, осуществляющие надзор за появлением и распространением в лесу наиболее опасных заболеваний. Они выявляют очаги инфекционных заболеваний, организуют лесоохранные мероприятия. Среди лесохозяйственных мероприятий большое значение имеют карантинные, направленные на предупреждение заноса возбудителей, ранее неизвестных в определенной местности, из областей их распространения. Ввозить растительный материал (семена, плоды, черенки, цветы) из одной страны в другую частным лицам строго запрещается. Ведь случайно с ними могут быть завезены опасные вредители и возбудители болезней растений. Например, в 1966 г. впервые в нашей стране, в Ленинградской обл. был обнаружен некроз плодов яблони, вызываемый микромицетом фиалофорой яблони. Впоследствии это заболевание распространилось на дикорастущие и культурные плодовые деревья и вызвало изменение структуры и окраски древесинных и сердцевинных тканей. До этого времени гриб был известен только в Англии, Голландии и США. Возможно, что кто-то завез в нашу страну это заболевание, сам того не ведая, с плодами яблок, поскольку ранее фиалофороз в нашей стране не был отмечен. Изящные мелкие грибки мицены осуществляют последнюю фазу разрушения древесины — гумификацию, когда она становится рыхлой и постепенно и постепенно покрывается мхами и травянистыми растениями
Большое значение имеют селекционно-семеноводческие методы предупреждения развития болезней. В их основе — выведение для разных зон нашей страны форм древесных пород, невосприимчивых к определенным заболеваниям, создание семенного фонда, соблюдение оптимальных режимов хранения и транспортировки семян. Уже созданы формы осины, устойчивые к ложному трутовику, "очкастого" осокоря, невосприимчивого к стволовым гнилям, и др.
Изящные мелкие грибки мицены осуществляют последнюю фазу разрушения древесины — гумификацию, когда она становится рыхлой и постепенно и постепенно покрывается мхами и травянистыми растениями
Большое значение имеют селекционно-семеноводческие методы предупреждения развития болезней. В их основе — выведение для разных зон нашей страны форм древесных пород, невосприимчивых к определенным заболеваниям, создание семенного фонда, соблюдение оптимальных режимов хранения и транспортировки семян. Уже созданы формы осины, устойчивые к ложному трутовику, "очкастого" осокоря, невосприимчивого к стволовым гнилям, и др.
 Сотни мелких плодовых тел псатиреллы рассеянной покрывают поваленное дерево или кучу валежных ветвей
Лесохозяйственные мероприятия включают различные меры по созданию благоприятных условий для роста и развития лесных пород на всех этапах их жизни. Наиболее важные их них — подбор здорового посевного и посадочного материала при лесоразведении и восстановлении леса, выращивание здорового посадочного материала в питомниках с соблюдением правил агротехники и с учетом поражаемости выращиваемых лесных пород одноименными возбудителями. Например, березу и лиственницу нежелательно выращивать в одних и тех же питомниках, так как они поражаются одним и тем же ржавчинным грибом, паразитирующим на этих породах в разных стадиях. В лесной фитопатологии для борьбы с возбудителями болезней леса применяют фунгициды, а для защиты древесины от гниения — антисептики. Фунгициды применяют для протравливания (обеззараживания и дезинфекции) семян при высадке их в почву, для опыливания и опрыскивания растений против возбудителей. С помощью водорастворимых, маслянистых, комбинированных антисептиков и антисептических паст защищают от гниения лесоматериалы в постройках, промышленных сооружениях, в шахтах и т. п. Довольно часто антисептические пасты используют для защиты городских и заповедных парков, пастами замазывают раны и дупла после обрезки пораженных ветвей, используют антисептики при удалении с деревьев ведьминых метел, плодовых тел трутовиков. При работе с пестицидами необходимо соблюдать меры предосторожности, так как эти вещества не безвредны для человека.
Сотни мелких плодовых тел псатиреллы рассеянной покрывают поваленное дерево или кучу валежных ветвей
Лесохозяйственные мероприятия включают различные меры по созданию благоприятных условий для роста и развития лесных пород на всех этапах их жизни. Наиболее важные их них — подбор здорового посевного и посадочного материала при лесоразведении и восстановлении леса, выращивание здорового посадочного материала в питомниках с соблюдением правил агротехники и с учетом поражаемости выращиваемых лесных пород одноименными возбудителями. Например, березу и лиственницу нежелательно выращивать в одних и тех же питомниках, так как они поражаются одним и тем же ржавчинным грибом, паразитирующим на этих породах в разных стадиях. В лесной фитопатологии для борьбы с возбудителями болезней леса применяют фунгициды, а для защиты древесины от гниения — антисептики. Фунгициды применяют для протравливания (обеззараживания и дезинфекции) семян при высадке их в почву, для опыливания и опрыскивания растений против возбудителей. С помощью водорастворимых, маслянистых, комбинированных антисептиков и антисептических паст защищают от гниения лесоматериалы в постройках, промышленных сооружениях, в шахтах и т. п. Довольно часто антисептические пасты используют для защиты городских и заповедных парков, пастами замазывают раны и дупла после обрезки пораженных ветвей, используют антисептики при удалении с деревьев ведьминых метел, плодовых тел трутовиков. При работе с пестицидами необходимо соблюдать меры предосторожности, так как эти вещества не безвредны для человека.
 Поселяясь на торцах пней, кориолус многоцветный образует красивые розетки плодовых тел
Лес нуждается в постоянном уходе, который осуществляется в насаждениях разного возраста. Особое место при этом отводят изъятию из насаждений возбудителей заболеваний. В городских парках и заповедных рощах осенью собирают и сжигают опавшие листья, так как часто они служат местом зимовки паразитных грибов-микромицетов и, следовательно, опасным резервом заболевания деревьев весной.
Поселяясь на торцах пней, кориолус многоцветный образует красивые розетки плодовых тел
Лес нуждается в постоянном уходе, который осуществляется в насаждениях разного возраста. Особое место при этом отводят изъятию из насаждений возбудителей заболеваний. В городских парках и заповедных рощах осенью собирают и сжигают опавшие листья, так как часто они служат местом зимовки паразитных грибов-микромицетов и, следовательно, опасным резервом заболевания деревьев весной.
 Плодовые тела трутовиков появляются обычно на значительно разложенной ими древесине
В лесах обычно проводят рубки в ходе которых заготавливается древесина, используемая в народном хозяйстве. При рубках ухода лес очищается от мертвых, ослабленных и зараженных вредителями и болезнями деревьев, а также деревьев и кустарников — передатчиков возбудителей заболеваний. В основном эти рубки связаны с биологическим отбором зрелых деревьев, санитарными прочистками и прорубами для осветления леса, что необходимо для восстановления леса. В зрелых древостоях проводят рубки главного пользования с соблюдением основ охраны и восстановления леса.
Плодовые тела трутовиков появляются обычно на значительно разложенной ими древесине
В лесах обычно проводят рубки в ходе которых заготавливается древесина, используемая в народном хозяйстве. При рубках ухода лес очищается от мертвых, ослабленных и зараженных вредителями и болезнями деревьев, а также деревьев и кустарников — передатчиков возбудителей заболеваний. В основном эти рубки связаны с биологическим отбором зрелых деревьев, санитарными прочистками и прорубами для осветления леса, что необходимо для восстановления леса. В зрелых древостоях проводят рубки главного пользования с соблюдением основ охраны и восстановления леса.
 Лес, как и сад, нуждается в постоянном уходе. Только защищенный от болезней и вредителей он радует нас своей красотой и свежестью
В большой степени скорость разложения древесного опада в лесу зависит, как уже упоминалось, от состава грибов — санитаров леса, их ферментативной активности и микроклиматических условий.
Лес, как и сад, нуждается в постоянном уходе. Только защищенный от болезней и вредителей он радует нас своей красотой и свежестью
В большой степени скорость разложения древесного опада в лесу зависит, как уже упоминалось, от состава грибов — санитаров леса, их ферментативной активности и микроклиматических условий.
 Лес, как и сад, нуждается в постоянном уходе. Только защищенный от болезней и вредителей он радует нас своей красотой и свежестью
Защита леса — дело каждого из нас. Идя в лес, мы должны помнить, что брошенный окурок или непогашенный костер грозит бедой. От неосторожного обращения с огнем могут выгореть огромные площади леса, восстановление которых требует больших затрат и многих лет! Гуляя в лесу, не ломайте ветви, ведь ранки на ветвях, стволах — ворота для инфекции, через них мицелий грибов внедряется в древесину и начинает свою разрушительную деятельность. Будьте другом леса, а не его врагом! И лес ответит благодарностью, защитив почву и пески от выветривания, а склоны гор и оврагов от эрозии, реки и озера от высыхания. Много радостных минут, прохлады и покоя он доставит вам во время отдыха!
Лес, как и сад, нуждается в постоянном уходе. Только защищенный от болезней и вредителей он радует нас своей красотой и свежестью
Защита леса — дело каждого из нас. Идя в лес, мы должны помнить, что брошенный окурок или непогашенный костер грозит бедой. От неосторожного обращения с огнем могут выгореть огромные площади леса, восстановление которых требует больших затрат и многих лет! Гуляя в лесу, не ломайте ветви, ведь ранки на ветвях, стволах — ворота для инфекции, через них мицелий грибов внедряется в древесину и начинает свою разрушительную деятельность. Будьте другом леса, а не его врагом! И лес ответит благодарностью, защитив почву и пески от выветривания, а склоны гор и оврагов от эрозии, реки и озера от высыхания. Много радостных минут, прохлады и покоя он доставит вам во время отдыха!
Грибы и сельскохозяйственные растения
 Человек постоянно вынужден охранять урожай от грибов-паразитов
Болезни возделываемых человеком растений, вызываемые грибами, известны с незапамятных времен. Достоверные исторические сведения о них появились за 3-4 тыс. лет до нашей эры. В книгах древнегреческих ученых Аристртеля, Демокрита и др. есть указания о ржавчине и головне хлебов и других болезнях растений. В то же время были известны лишь признаки болезней, причины же их трактовались неправильно. Сведения о болезнях растений долго носили эмпирический характер, однако часто имели практическую направленность. Так, рекомендовалось обрабатывать семена пшеницы в растворе вина с толчеными листьями кипариса или в соленой морской воде. Такая обработка помогала якобы уничтожить головню.
Постепенно познавалась инфекционная природа некоторых болезней растений. Однако на научную основу наука о болезнях растений (фитопатология) была поставлена лишь в первой половине XIX в., когда была доказана инфекционная природа многих болезней растений, установлено, что они вызываются паразитными грибами, выявлен цикл развития возбудителей в природе. Были проведены исследования по ржавчине хлебных злаков и фасоли, головневым болезням хлебных злаков, фитофторозу картофеля и др. На основании этих данных стало возможным рекомендовать эффективные меры борьбы с грибными болезнями растений. Наука о болезнях растений с тех пор стала быстро развиваться и в настоящее время разрослась в самостоятельную дисциплину, в которой большое место занимает учение о грибных болезнях растений. Выдающееся место в развитии фитопатологии принадлежит в нашей стране ученым М. С. Воронину, А. А. Ячевскому, Н. А. Наумову и др.
Человек постоянно вынужден охранять урожай от грибов-паразитов
Болезни возделываемых человеком растений, вызываемые грибами, известны с незапамятных времен. Достоверные исторические сведения о них появились за 3-4 тыс. лет до нашей эры. В книгах древнегреческих ученых Аристртеля, Демокрита и др. есть указания о ржавчине и головне хлебов и других болезнях растений. В то же время были известны лишь признаки болезней, причины же их трактовались неправильно. Сведения о болезнях растений долго носили эмпирический характер, однако часто имели практическую направленность. Так, рекомендовалось обрабатывать семена пшеницы в растворе вина с толчеными листьями кипариса или в соленой морской воде. Такая обработка помогала якобы уничтожить головню.
Постепенно познавалась инфекционная природа некоторых болезней растений. Однако на научную основу наука о болезнях растений (фитопатология) была поставлена лишь в первой половине XIX в., когда была доказана инфекционная природа многих болезней растений, установлено, что они вызываются паразитными грибами, выявлен цикл развития возбудителей в природе. Были проведены исследования по ржавчине хлебных злаков и фасоли, головневым болезням хлебных злаков, фитофторозу картофеля и др. На основании этих данных стало возможным рекомендовать эффективные меры борьбы с грибными болезнями растений. Наука о болезнях растений с тех пор стала быстро развиваться и в настоящее время разрослась в самостоятельную дисциплину, в которой большое место занимает учение о грибных болезнях растений. Выдающееся место в развитии фитопатологии принадлежит в нашей стране ученым М. С. Воронину, А. А. Ячевскому, Н. А. Наумову и др.
Болезни зерновых культур, вызываемые грибами
Хорошо известны болезни зерновых культур, особенно часто вызываемые ржавчинными и головневыми грибами. Одна из них — стеблевая ржавчина злаков, проявляющаяся на стеблях в виде продольных пустул (споровместилищ) сначала бурых, кирпично-красных, а позднее черных. В местах появления пустул эпидермис разрывается. У возбудителя стеблевой ржавчины довольно узкая специализация — способность заражать какой-либо один вид или группу близких видов злаков. Есть пшеничная, ржаная, овсяная и другие формы возбудителя. Интересно, что отдельные формы гриба различаются не только по специализации, но и по биологическим особенностям. Форма, паразитирующая на ржи, ячмене и диких видах пырея, зимует или на озимой ржи или в корневищах некоторых видов пырея. Развивающиеся весной на этих растениях споры ржавчины заражают сначала растения, находящиеся вблизи тех, на которых гриб перезимовал, а затем уже распространяются по всему полю. Ячмень заражается ржавчиной со ржи или пырея. В некоторых местах, например на северо-западе СССР, ржаная форма паразита проходит полный цикл развития. Там рожь поражается от весенних спор, которые образуются на промежуточном хозяине возбудителя стеблевой ржавчины — барбарисе. Форма, паразитирующая на пшенице, чаще всего тоже проходит полный цикл развития. Гриб зимует в виде зимних спор на стерне и соломе. Весной они прорастают, образуют споры, которые заражают барбарис, где развиваются весенние споры, с помощью которых гриб переходит на пшеницу. В некоторых местах происходит своеобразное ступенчатое развитие возбудителя стеблевой ржавчины. Она переходит на пшеницу не с барбариса, а с дикорастущих злаков. В некоторых районах возбудитель стеблевой ржавчины перезимовывает на дикорастущих злаках, а весной с них переходит на пшеницу. Не исключена перезимовка возбудителя и на озимой пшенице. Большой вред пшенице приносит бурая листовая ржавчина, развивающаяся на листьях и листовых влагалищах, на которых появляются небольшие бурые пустулы — скопления летних спор, выступающих из прорванной кожицы листьев. Гриб зимует на посевах озимой пшеницы, которые заражаются осенью летними спорами с падалицы или с остатков растений, оставшихся после уборки. Сильное развитие бурой ржавчины происходит при влажной, теплой погоде. В районах, где преобладают яровые пшеницы, развитие бурой ржавчины связано с промежуточным хозяином (лещицей), который поражается весенней стадией гриба, переходящей затем на пшеницу. Зерновые культуры местами, особенно в сравнительно прохладные годы, поражаются также желтой ржавчиной. Возбудитель ее зимует на посевах и самосеве озимой пшеницы и на некоторых дикорастущих злаках (костре кровельном, плевеле опьяняющем и др.). Для борьбы с ржавчиной зерновых культур применяются агротехнические мероприятия, снижающие количество инфекции, а также выращивание устойчивых сортов. Еще с глубокой древности была известна головня хлебных злаков. Болезнь поражает зерновки, которые превращаются в темную пылящую или мажущуюся массу головневых спор. Реже головня появляется на листьях или стеблях (стеблевая головня) в виде продольных черных полос. В месте поражения ткань разрывается — и споры гриба высыпаются наружу, заражая семена. На пшенице встречаются твердая, или вонючая, и пыльная, реже стеблевая головня, на ржи стеблевая, редко твердая, на ячмене пыльная и твердая, или каменная, на просе пыльная и на кукурузе пузырчатая головня. Головней поражается также овес. 1 — твердая головня пшеницы(пораженные колос и зерновка, спора гриба); 2 — пыльная головня пшеницы
Пшеница, ячмень, просо и овес заражаются головней в период прорастания семян. Головневые споры, находящиеся на поверхности семян или под пленками (у проса и овса), прорастают, образуя споры, ростки которых проникают в ткани проростков, распространяясь по межклеточникам, подвигаются кверху, достигая колоса, где вместо зерен образуется масса головневых спор. Поскольку заразное начало у всех указанных головневых грибов находится на поверхности семян, бороться с ними можно путем протравливания семян химикатами. Против головни пшеницы и ржи применяется сухой способ обработки семян, а против головни проса и овса — сухая и влажная обработка. Сухое протравливание ведется гранозаном (1,5 кг на 1т семян), пентахлорнитробензолом (ПХНБ) (2 кг) и ТМТД (1,5-2 кг на 1 т). Влажную обработку следует проводить раствором формалина в пропорции 1:300 или 1:80. Для улучшения прилипаемости сухих протравителей лучше использовать суспензии сухих препаратов с нормой расхода воды 5-25 л на 1 т семян. Зерно, обработанное сухими протравителями, ядовито, поэтому в пищу, на корм скоту и птице непригодно.
1 — твердая головня пшеницы(пораженные колос и зерновка, спора гриба); 2 — пыльная головня пшеницы
Пшеница, ячмень, просо и овес заражаются головней в период прорастания семян. Головневые споры, находящиеся на поверхности семян или под пленками (у проса и овса), прорастают, образуя споры, ростки которых проникают в ткани проростков, распространяясь по межклеточникам, подвигаются кверху, достигая колоса, где вместо зерен образуется масса головневых спор. Поскольку заразное начало у всех указанных головневых грибов находится на поверхности семян, бороться с ними можно путем протравливания семян химикатами. Против головни пшеницы и ржи применяется сухой способ обработки семян, а против головни проса и овса — сухая и влажная обработка. Сухое протравливание ведется гранозаном (1,5 кг на 1т семян), пентахлорнитробензолом (ПХНБ) (2 кг) и ТМТД (1,5-2 кг на 1 т). Влажную обработку следует проводить раствором формалина в пропорции 1:300 или 1:80. Для улучшения прилипаемости сухих протравителей лучше использовать суспензии сухих препаратов с нормой расхода воды 5-25 л на 1 т семян. Зерно, обработанное сухими протравителями, ядовито, поэтому в пищу, на корм скоту и птице непригодно.
 Пузырчатая головня кукурузы(пораженный початок)
Пшеница и ячмень заражаются пыльной головней во время цветения. Споры гриба попадают на рыльца цветков, проникают в развивающуюся завязь и затем в зерновку. Мицелий гриба распространяется в зону зародыша и в поверхностные ткани семени. Весной после прорастания семян мицелий трогается в рост и проникает в молодые растения, но не снаружи, а из внутренней части семени. Затем гриб распространяется внутри тканей растения, достигает колоса и уничтожает семена — вместо них образуется пылящая масса спор, которые рассеиваются в воздухе, попадают на цветки, вновь вызывая заражение. Рассеивание спор приурочено как раз ко времени цветения пшеницы и ячменя.
Для борьбы с пыльной головней производят тепловую обработку семян или обеззараживают их витаваксом (при норме 2,5-3 кг/т) или фундазолом (2-3 кг/т). • Кукуруза заражается пузырчатой головней. В отличие от описанных выше головневых болезней пузырчатая головня проявляется на листьях, стеблях, початках, султанах кукурузы в виде вздутий (пузырей) разного размера, наполненных черной массой головневых спор. Заражается кукуруза от спор, сохранившихся на остатках растений или распыленных на поверхности почвы. Особенно большой вред эта головня наносит молодым растениям.
Для борьбы с пузырчатой головней рекомендуется уничтожение на поле послеуборочных остатков, зяблевая пахота. Хорошие результаты дает применение микроэлементов. Более устойчивы к пузырчатой головне межлинейные гибриды кукурузы.
Зерновые культуры страдают от корневых гнилей. Наиболее распространена обыкновенная корневая гниль, поражающая многие виды культурных и дикорастущих злаков, особенно яровую пшеницу и ячмень. Возбудители корневых гнилей — грибы из родов гельминтоспориум и фузариум могут сохраняться в почве и на растительных остатках, в семенах злаков. В разных районах значение указанных источников заражения растений различно.
Пузырчатая головня кукурузы(пораженный початок)
Пшеница и ячмень заражаются пыльной головней во время цветения. Споры гриба попадают на рыльца цветков, проникают в развивающуюся завязь и затем в зерновку. Мицелий гриба распространяется в зону зародыша и в поверхностные ткани семени. Весной после прорастания семян мицелий трогается в рост и проникает в молодые растения, но не снаружи, а из внутренней части семени. Затем гриб распространяется внутри тканей растения, достигает колоса и уничтожает семена — вместо них образуется пылящая масса спор, которые рассеиваются в воздухе, попадают на цветки, вновь вызывая заражение. Рассеивание спор приурочено как раз ко времени цветения пшеницы и ячменя.
Для борьбы с пыльной головней производят тепловую обработку семян или обеззараживают их витаваксом (при норме 2,5-3 кг/т) или фундазолом (2-3 кг/т). • Кукуруза заражается пузырчатой головней. В отличие от описанных выше головневых болезней пузырчатая головня проявляется на листьях, стеблях, початках, султанах кукурузы в виде вздутий (пузырей) разного размера, наполненных черной массой головневых спор. Заражается кукуруза от спор, сохранившихся на остатках растений или распыленных на поверхности почвы. Особенно большой вред эта головня наносит молодым растениям.
Для борьбы с пузырчатой головней рекомендуется уничтожение на поле послеуборочных остатков, зяблевая пахота. Хорошие результаты дает применение микроэлементов. Более устойчивы к пузырчатой головне межлинейные гибриды кукурузы.
Зерновые культуры страдают от корневых гнилей. Наиболее распространена обыкновенная корневая гниль, поражающая многие виды культурных и дикорастущих злаков, особенно яровую пшеницу и ячмень. Возбудители корневых гнилей — грибы из родов гельминтоспориум и фузариум могут сохраняться в почве и на растительных остатках, в семенах злаков. В разных районах значение указанных источников заражения растений различно.
 Стебель кукурузы, пораженный пузырчатой головней
Для подавления развития корневых гнилей необходимо правильное чередование культур в севообороте, применение органических и минеральных удобрений, оптимальные для данного района сроки сева, борьба с сорняками, особенно злаковыми, и другие агротехнические мероприятия. Эффективно также применение биологического препарата триходермина, обработка семян ТМТД (при норме 1,5 кг/т), гектахлорбензолом с гептахлором или гептагексаном (2 кг/т); последние два препарата подавляют развитие твердой головни и почвообитающих вредителей.
Стебель кукурузы, пораженный пузырчатой головней
Для подавления развития корневых гнилей необходимо правильное чередование культур в севообороте, применение органических и минеральных удобрений, оптимальные для данного района сроки сева, борьба с сорняками, особенно злаковыми, и другие агротехнические мероприятия. Эффективно также применение биологического препарата триходермина, обработка семян ТМТД (при норме 1,5 кг/т), гектахлорбензолом с гептахлором или гептагексаном (2 кг/т); последние два препарата подавляют развитие твердой головни и почвообитающих вредителей.
Болезни овощных культур
Возбудитель болезни фитофтороза картофеля и томатов — гриб фитофтора инфестанс — был завезен в Европу из Южной Америки. Этот гриб паразитирует на картофеле и томатах, причем у последних поражает главным образом плоды. На листьях картофеля фитофтороз проявляется в виде бурых пятен, часто расположенных по краю листа. На нижней стороне пятен во влажную погоду или рано утром, если выпадает роса, по краю пятен появляется белый налет, состоящий из спор и грибницы возбудителя. При теплой влажной погоде заболевание распространяется на черешки листьев и стебли, что приводит к гибели растений. Клубни заражаются от больных листьев или во время уборки при соприкосновении клубней с зараженной фитофторозом ботвой или в период роста картофеля в поле. Вместе с каплями дождя споры гриба-возбудителя смываются на почву и попадают на клубни, вызывая их заражение. На клубнях картофеля фитофтороз проявляется в виде бурых с фиолетовым оттенком слегка вдавленных пятен. На разрезе зараженного клубня видно, что мякоть в месте проявления болезни темно-коричневая, слегка проникающая в толщу клубня. Основной источник заражения картофеля фитофторозом — больные посадочные клубни. Они дают зараженные ростки, от которых болезнь распространяется на соседние растения. Массовое поражение картофеля фитофторозом может произойти при наличии одного зараженного ростка на 1 км2 поля. Поэтому очень важен тщательный отбор посадочных клубней картофеля. Фитофтороз картофеля
Очень важным источником заражения картофеля фитофторозом служат выбракованные кучи клубней. Образующиеся на таких клубнях ростки могут быть первичными очагами болезни.
Томаты заражаются от больного картофеля, поэтому их не следует высаживать рядом с картофелем, при посадке их надо разделять высокостебельными растениями, например кукурузой или подсолнечником. Для развития фитофтороза картофеля и томатов благоприятна влажная теплая погода, особенно в конце июля — начале августа.
Фитофтороз картофеля
Очень важным источником заражения картофеля фитофторозом служат выбракованные кучи клубней. Образующиеся на таких клубнях ростки могут быть первичными очагами болезни.
Томаты заражаются от больного картофеля, поэтому их не следует высаживать рядом с картофелем, при посадке их надо разделять высокостебельными растениями, например кукурузой или подсолнечником. Для развития фитофтороза картофеля и томатов благоприятна влажная теплая погода, особенно в конце июля — начале августа.
 Фитофтороз томатов
Для борьбы с фитофторозом картофеля и томатов большое значение имеют мероприятия, направленные на уничтожение источников инфекции: скашивание и уничтожение ботвы картофеля незадолго до уборки, уничтожение мест свалки зараженных-клубней картофеля и плодов томатов до появления всходов картофеля в поле. Перед закладкой картофеля на хранение хранилища следует дезинфицировать 2- 3%-ным раствором медного купороса с известью или раствором формалина (1 : 300) из расчета 20-25 мл раствора на 1 м3 помещения. Необходимо тщательно очищать участки, предназначенные для посадки картофеля и томатов, от остатков ботвы и стеблей сорняков. Участки следует перепахивать с оборотом пласта. Большое значение имеет также выращивание устойчивых сортов картофеля: Лорх, Темп, Любимец, Столовый 19, Гатчинский, Камераз и др. Эффективно опрыскивание ботвы во время вегетации. Первое опрыскивание проводят по сигналу ближайшего наблюдательного пункта службы учета, но не раньше, чем в период бутонизации и цветения. Лучшие результаты дает опрыскивание бордоской жидкостью, хлор-окисью меди, цинебом, купрозаном (норма расхода 400-600 л/га).
Капуста и другие крестоцветные подвержены заболеванию килой. Болезнь поражает корни, на которых образуются разной величины наросты, причем они могут появляться еще на рассаде. Иногда растения заражаются и после высадки их в грунт. Источники заражения накапливаются в почве, куда попадают после сгнивания наростов, оставшихся в поле после уборки капусты. Гриб — возбудитель заболевания проникает в корни растений через корневые волоски или клетки поверхностного слоя корня. При сильном развитии на корнях наростов затрудняется подача из почвы воды и минеральных веществ, и в жаркую погоду больные растения подвядают. Возбудитель килы поражает до 200 видов крестоцветных, чаще белокачанную капусту, редис, репу, а из сорняков пастушью сумку. Наиболее подвержены заболеванию капуста при возделывании ее в течение ряда лет на одном и том же месте, а также крестоцветные, растущие на кислых почвах. Поэтому мерами борьбы с этой болезнью являются соответственно чередование посадок капусты с другими (не крестоцветными) культурами и известкование кислых почв. Необходимо также после сбора урожая уничтожать капустные кочерыги, сорныерастения, браковать больную рассаду.
Фитофтороз томатов
Для борьбы с фитофторозом картофеля и томатов большое значение имеют мероприятия, направленные на уничтожение источников инфекции: скашивание и уничтожение ботвы картофеля незадолго до уборки, уничтожение мест свалки зараженных-клубней картофеля и плодов томатов до появления всходов картофеля в поле. Перед закладкой картофеля на хранение хранилища следует дезинфицировать 2- 3%-ным раствором медного купороса с известью или раствором формалина (1 : 300) из расчета 20-25 мл раствора на 1 м3 помещения. Необходимо тщательно очищать участки, предназначенные для посадки картофеля и томатов, от остатков ботвы и стеблей сорняков. Участки следует перепахивать с оборотом пласта. Большое значение имеет также выращивание устойчивых сортов картофеля: Лорх, Темп, Любимец, Столовый 19, Гатчинский, Камераз и др. Эффективно опрыскивание ботвы во время вегетации. Первое опрыскивание проводят по сигналу ближайшего наблюдательного пункта службы учета, но не раньше, чем в период бутонизации и цветения. Лучшие результаты дает опрыскивание бордоской жидкостью, хлор-окисью меди, цинебом, купрозаном (норма расхода 400-600 л/га).
Капуста и другие крестоцветные подвержены заболеванию килой. Болезнь поражает корни, на которых образуются разной величины наросты, причем они могут появляться еще на рассаде. Иногда растения заражаются и после высадки их в грунт. Источники заражения накапливаются в почве, куда попадают после сгнивания наростов, оставшихся в поле после уборки капусты. Гриб — возбудитель заболевания проникает в корни растений через корневые волоски или клетки поверхностного слоя корня. При сильном развитии на корнях наростов затрудняется подача из почвы воды и минеральных веществ, и в жаркую погоду больные растения подвядают. Возбудитель килы поражает до 200 видов крестоцветных, чаще белокачанную капусту, редис, репу, а из сорняков пастушью сумку. Наиболее подвержены заболеванию капуста при возделывании ее в течение ряда лет на одном и том же месте, а также крестоцветные, растущие на кислых почвах. Поэтому мерами борьбы с этой болезнью являются соответственно чередование посадок капусты с другими (не крестоцветными) культурами и известкование кислых почв. Необходимо также после сбора урожая уничтожать капустные кочерыги, сорныерастения, браковать больную рассаду.
 Кила капусты и ложная мучнистая роса лука
К одной из самых вредоносных болезней лука относится пероноспороз, или ложная мучнистая роса. При сильном поражении листья лука желтеют и засыхают, покрываясь светло-фиолетовым налетом, состоящим из спороношений гриба — возбудителя болезни. Иногда болезнь проявляется в виде отдельных пятен. Возможно также нетипичное, скрытое проявление болезни на луке первого года жизни (к концу июля — началу августа) в виде мраморности листьев и цветоносов, мелких некротических точек, гофрированности листьев; поражаются также соцветия и корневая система.
У гриба — возбудителя пероноспороза различают два типа мицелия, вызывающих разные формы болезни, которая передается с семенами и зараженными луковицами. Из семян и из луковиц гриб переходит в вегетативные части растений, вызывая те или иные типы заражения. Возможна зимовка гриба в зараженных листьях лука, где образуются ооспоры, прорастающие весной и заражающие растения. При этом на листьях появляются локальные поражения в виде пятен. Возбудитель пероноспороза заражает многие виды лука: батун, шнитт-лук и др. В корнях многолетних видов лука паразит может перезимовывать.
Меры борьбы с пероноспорозом состоят в соблюдении севооборотов, уничтожении прошлогодних остатков растений. Луковицы перед посадкой следует прогревать осенью или весной сухим жаром при температуре 40oС в течение 8, 10, 24 ч (время прогрева зависит от размера луковиц). Эффективна прочистка заболевших растений, опрыскивание растений бордоской ж пакостью или ее заменителями с добавлением веществ, способствующих удержанию препарата на растениях.
Кила капусты и ложная мучнистая роса лука
К одной из самых вредоносных болезней лука относится пероноспороз, или ложная мучнистая роса. При сильном поражении листья лука желтеют и засыхают, покрываясь светло-фиолетовым налетом, состоящим из спороношений гриба — возбудителя болезни. Иногда болезнь проявляется в виде отдельных пятен. Возможно также нетипичное, скрытое проявление болезни на луке первого года жизни (к концу июля — началу августа) в виде мраморности листьев и цветоносов, мелких некротических точек, гофрированности листьев; поражаются также соцветия и корневая система.
У гриба — возбудителя пероноспороза различают два типа мицелия, вызывающих разные формы болезни, которая передается с семенами и зараженными луковицами. Из семян и из луковиц гриб переходит в вегетативные части растений, вызывая те или иные типы заражения. Возможна зимовка гриба в зараженных листьях лука, где образуются ооспоры, прорастающие весной и заражающие растения. При этом на листьях появляются локальные поражения в виде пятен. Возбудитель пероноспороза заражает многие виды лука: батун, шнитт-лук и др. В корнях многолетних видов лука паразит может перезимовывать.
Меры борьбы с пероноспорозом состоят в соблюдении севооборотов, уничтожении прошлогодних остатков растений. Луковицы перед посадкой следует прогревать осенью или весной сухим жаром при температуре 40oС в течение 8, 10, 24 ч (время прогрева зависит от размера луковиц). Эффективна прочистка заболевших растений, опрыскивание растений бордоской ж пакостью или ее заменителями с добавлением веществ, способствующих удержанию препарата на растениях.
Болезни плодовых культур
В 1872 г. в Европу из Америки была завезена болезнь винограда — мильдью (ложная мучнистая роса), а в 1886 г. она появилась и в России на Кавказе. Мильдью поражает зеленые части виноградного куста: весной и летом на листьях развиваются крупные желтоватые маслянистые пятна, которые позже буреют, и ткань листа в месте заражения засыхает. Осенние пятна на листьях мелкие, угловатые, ограниченные жилками. Поражаются также побеги, цветки, завязи и ягоды. Возбудитель мильдью зимует в опавших зараженных листьях, где в результате полового процесса развиваются зимующие споры (ооспоры). Весной ооспоры освобождаются от тканей и после выпадения дождей и повышения температуры прорастают в ростковую трубку с микроконидией на вершине. При попадании ее на поверхность листа винограда в ней образуются зооспоры, плавающие в каплях воды. Затем у них развивается ростковая трубка, при помощи которой через устьица гриб проникает в ткани листка. Ткань листа отмирает, на ней развиваются описанные выше пятна. Во влажную погоду на пятнах образуются спороношения гриба. Содержимое их выходит наружу в виде подвижных спор (зооспор) или плазмы, проникающих в ткани и вызывающих новые заражения. За лето образуется несколько поколений гриба. Время, протекающее между двумя поколениями, называется инкубационным периодом. Чем короче инкубационный период, тем чаще происходят новые заражения, и виноград сильнее поражается мильдью. Длина инкубационного периода зависит от температуры воздуха. Например, при температуре воздуха 11-13oС он равен 10-12, а при 21-27oС 4-5 дням. Следовательно, при более высокой температуре новые заражения винограда мильдью происходят вдвое чаще, чем при более низкой. Мильдью(ложная мучнистая роса) винограда: пораженные лист и плоды
Наиболее сильно от мильдью страдают виноградники, расположенные в низких сырых местах, а также загущенные посадки. Это следует учесть при закладке новых виноградников.
Для борьбы с мильдью надо уничтожать опавшие листья и перекапывать почву. Полезно также весной, тотчас после открытия кустов после зимовки опрыскивать их и почву под ними в рядах и междурядьях 2-3%-ным раствором нитрофена (расход жидкости 1000-3000 г/га). Такое опрыскивание эффективно и против других болезней винограда. Для борьбы с мильдью в период вегетации опрыскивают виноградники химикатами, учитывая особенности развития болезни в том или ином году. Опрыскивание повторяют после появления у растений нового прироста, не защищенного химикатом. Лучший препарат для борьбы с мильдью — бордоская жидкость. Применяют также другие препараты. Обычно растения обрабатывают 5-7 раз. Устойчивы к мильдью сорта винограда типа "Изабелла" или группы "Лидия".
Из болезней семечковых плодовых культур широко распространена парша яблони. Эта болезнь поражает листья и плоды, а у груши и побеги. На листьях образуются небольшие круглые пятна с бархатистым налетом с нижней стороны листа, а на плодах — небольшие пятна опробковевшей ткани. При сильном поражении пятна в местах развития парши растрескиваются. Особенно часто это бывает у плодов груши. Гриб — возбудитель парши имеет две стадии развития, первая развивается на опавших листьях, а вторая на живых.
Основной источник заражения паршой — опавшие листья, с которых весной заражение передается на листья здоровых деревьев. Степень поражения яблонь паршой зависит от количества сохранившегося на листьях инфекционного начала (спор гриба-возбудителя) и от благоприятных условий для развития конидий. Наиболее сильно яблони и груши страдают от парши в относительно теплые, с часто перепадающими небольшими дождями и росами годы.
Мильдью(ложная мучнистая роса) винограда: пораженные лист и плоды
Наиболее сильно от мильдью страдают виноградники, расположенные в низких сырых местах, а также загущенные посадки. Это следует учесть при закладке новых виноградников.
Для борьбы с мильдью надо уничтожать опавшие листья и перекапывать почву. Полезно также весной, тотчас после открытия кустов после зимовки опрыскивать их и почву под ними в рядах и междурядьях 2-3%-ным раствором нитрофена (расход жидкости 1000-3000 г/га). Такое опрыскивание эффективно и против других болезней винограда. Для борьбы с мильдью в период вегетации опрыскивают виноградники химикатами, учитывая особенности развития болезни в том или ином году. Опрыскивание повторяют после появления у растений нового прироста, не защищенного химикатом. Лучший препарат для борьбы с мильдью — бордоская жидкость. Применяют также другие препараты. Обычно растения обрабатывают 5-7 раз. Устойчивы к мильдью сорта винограда типа "Изабелла" или группы "Лидия".
Из болезней семечковых плодовых культур широко распространена парша яблони. Эта болезнь поражает листья и плоды, а у груши и побеги. На листьях образуются небольшие круглые пятна с бархатистым налетом с нижней стороны листа, а на плодах — небольшие пятна опробковевшей ткани. При сильном поражении пятна в местах развития парши растрескиваются. Особенно часто это бывает у плодов груши. Гриб — возбудитель парши имеет две стадии развития, первая развивается на опавших листьях, а вторая на живых.
Основной источник заражения паршой — опавшие листья, с которых весной заражение передается на листья здоровых деревьев. Степень поражения яблонь паршой зависит от количества сохранившегося на листьях инфекционного начала (спор гриба-возбудителя) и от благоприятных условий для развития конидий. Наиболее сильно яблони и груши страдают от парши в относительно теплые, с часто перепадающими небольшими дождями и росами годы.
 Яблоки, пораженные паржой
Паршой заражаются также дикорастущие яблони, от которых могут заболевать культурные формы.
Для борьбы с паршой следует уничтожать опавшие листья с осени или ранней весной, перекапывать междурядья и приствольные круги; полезно ранневесеннее опрыскивание опавших голых деревьев нитрофеном или солиноном. При этом на опавших листьях гибнет зимующая стадия гриба. Весной и летом деревья опрыскивают бордоской жидкостью или цинебом.
Мучнистая роса поражает однолетние побеги, цветки и завязи яблони. Заболевшие побеги деформируются, покрываются белым мучнистым налетом, почки развиваются медленней, образующиеся на них листья отстают в росте и отмирают, цветки деформируются, не дают завязи.
Яблоки, пораженные паржой
Паршой заражаются также дикорастущие яблони, от которых могут заболевать культурные формы.
Для борьбы с паршой следует уничтожать опавшие листья с осени или ранней весной, перекапывать междурядья и приствольные круги; полезно ранневесеннее опрыскивание опавших голых деревьев нитрофеном или солиноном. При этом на опавших листьях гибнет зимующая стадия гриба. Весной и летом деревья опрыскивают бордоской жидкостью или цинебом.
Мучнистая роса поражает однолетние побеги, цветки и завязи яблони. Заболевшие побеги деформируются, покрываются белым мучнистым налетом, почки развиваются медленней, образующиеся на них листья отстают в росте и отмирают, цветки деформируются, не дают завязи.
 Мучнистая роса яблони(пораженный побег)
Возбудитель мучнистой росы чаще зимует в почках в виде мицелия, а также на зараженных побегах. Весной грибница переходит на молодые побеги, образуя там спороношение, обеспечивающее дальнейшее развитие болезни.
Для борьбы с мучнистой росой рекомендуется обрезать и уничтожать пораженные побеги, перекапывать почву в саду, обрабатывать растения фунгицидами. Особенно эффективно сочетание обрезки пораженных побегов с обработкой деревьев химикатами.
Болезни стволов яблони и груши развиваются главным образом при плохом уходе за садом. Основное место среди них занимает черный рак, поражающий ветви и стволы деревьев. На коре появляются бурые вдавленные пятна, распространяющиеся и захватывающие значительную часть коры, пораженные ветви отмирают, а если поражается главный ствол, гибнет все дерево; заболевают также листья, цветки и плоды. Болезнь вызывается грибом из рода сферопсис. На погибших частях дерева образуются спороношения гриба, при помощи которых болезнь распространяется от одного дерева к другому. Особенно сильно страдают яблони. Гриб поражает преимущественно ослабленные или стареющие деревья. Усиливает распространение болезни подмерзание и растрескивание коры.
Мучнистая роса яблони(пораженный побег)
Возбудитель мучнистой росы чаще зимует в почках в виде мицелия, а также на зараженных побегах. Весной грибница переходит на молодые побеги, образуя там спороношение, обеспечивающее дальнейшее развитие болезни.
Для борьбы с мучнистой росой рекомендуется обрезать и уничтожать пораженные побеги, перекапывать почву в саду, обрабатывать растения фунгицидами. Особенно эффективно сочетание обрезки пораженных побегов с обработкой деревьев химикатами.
Болезни стволов яблони и груши развиваются главным образом при плохом уходе за садом. Основное место среди них занимает черный рак, поражающий ветви и стволы деревьев. На коре появляются бурые вдавленные пятна, распространяющиеся и захватывающие значительную часть коры, пораженные ветви отмирают, а если поражается главный ствол, гибнет все дерево; заболевают также листья, цветки и плоды. Болезнь вызывается грибом из рода сферопсис. На погибших частях дерева образуются спороношения гриба, при помощи которых болезнь распространяется от одного дерева к другому. Особенно сильно страдают яблони. Гриб поражает преимущественно ослабленные или стареющие деревья. Усиливает распространение болезни подмерзание и растрескивание коры.
 Черный рак яблони: пораженные ветка(1), листья и завязь(2), пикнида гриба(3)
Главное в борьбе с черным раком — создание условий для лучшего произрастания деревьев, нормальное их питание, своевременный полив, особенно в период формирования и созревания плодов. При первом появлении чернораковых язв весной пораженную кору очищают и обнаженную древесину смазывают карболинеумом, а через 5-6 дней рану покрывают известью или глиной. Вырезанную больную ткань необходимо уничтожать.
В западных районах СССР, особенно в Белоруссии, распространен обыкновенный рак яблони, вызываемый грибом рода нектрия. Болезнь поражает стволы, скелетные ветви, реже другие части дерева. Кора в пораженных местах вдавливается, пятно медленно разрастается, образуются наплывы, глубокие язвы. Гриб перезимовывает в пораженной коре. Обыкновенный рак больше вредит старым и ослабленным морозом или другими неблагоприятными факторами деревьям. Для борьбы с обыкновенным раком рекомендуется зачищать раны и обрабатывать их нигроловыми замазками. Большое значение имеет хороший уход за садом.
Садам из косточковых пород местами сильно вредит монилиальный ожог, или серая гниль плодов. Болезнь эта становится заметной уже весной и проявляется в побурении и отмирании бутонов, цветков, листьев, побегов и ветвей. Позднее заражаются завязи и крупные плоды. На пораженных частях растений развивается серый налет, состоящий из скопления спор возбудителя болезни — гриба монилии серой. Гриб зимует в пораженных ветвях или однолетних побегах в форме мицелия. Источником заражения могут быть и прошлогодние сгнившие плоды. Весной на больных частях растения развиваются спороношения гриба, вызывающие новые заражения. Ко времени цветения деревьев в воздухе накапливается большой запас спор паразита. Плоды заражаются серой гнилью только после повреждения кожицы. Особенно активно распространяет гниль плодов жук-казарка. Самки казарки во время яйцекладки вносят в плод споры гриба, вызывающие его гниение. В гниющей ткани хорошо развиваются личинки насекомого. Распространять плодовую гниль могут и другие насекомые.
Черный рак яблони: пораженные ветка(1), листья и завязь(2), пикнида гриба(3)
Главное в борьбе с черным раком — создание условий для лучшего произрастания деревьев, нормальное их питание, своевременный полив, особенно в период формирования и созревания плодов. При первом появлении чернораковых язв весной пораженную кору очищают и обнаженную древесину смазывают карболинеумом, а через 5-6 дней рану покрывают известью или глиной. Вырезанную больную ткань необходимо уничтожать.
В западных районах СССР, особенно в Белоруссии, распространен обыкновенный рак яблони, вызываемый грибом рода нектрия. Болезнь поражает стволы, скелетные ветви, реже другие части дерева. Кора в пораженных местах вдавливается, пятно медленно разрастается, образуются наплывы, глубокие язвы. Гриб перезимовывает в пораженной коре. Обыкновенный рак больше вредит старым и ослабленным морозом или другими неблагоприятными факторами деревьям. Для борьбы с обыкновенным раком рекомендуется зачищать раны и обрабатывать их нигроловыми замазками. Большое значение имеет хороший уход за садом.
Садам из косточковых пород местами сильно вредит монилиальный ожог, или серая гниль плодов. Болезнь эта становится заметной уже весной и проявляется в побурении и отмирании бутонов, цветков, листьев, побегов и ветвей. Позднее заражаются завязи и крупные плоды. На пораженных частях растений развивается серый налет, состоящий из скопления спор возбудителя болезни — гриба монилии серой. Гриб зимует в пораженных ветвях или однолетних побегах в форме мицелия. Источником заражения могут быть и прошлогодние сгнившие плоды. Весной на больных частях растения развиваются спороношения гриба, вызывающие новые заражения. Ко времени цветения деревьев в воздухе накапливается большой запас спор паразита. Плоды заражаются серой гнилью только после повреждения кожицы. Особенно активно распространяет гниль плодов жук-казарка. Самки казарки во время яйцекладки вносят в плод споры гриба, вызывающие его гниение. В гниющей ткани хорошо развиваются личинки насекомого. Распространять плодовую гниль могут и другие насекомые.
 Плодовая гниль яблок
Развитию серой гнили способствует прохладная, влажная погода весной, особенно частые дожди и туманы. Поражаются все виды косточковых плодовых деревьев. Для борьбы с этой болезнью необходимо осенью или ранней весной вырезать пораженные побеги. Следует также уничтожать оставшиеся на ветках сгнившие плоды, перекапывать почву. Эффективно опрыскивание деревьев бордоской жидкостью.
Еще одна болезнь косточковых пород — коккомикоз, получила название от гриба коккомицеса. Чаще всего ею поражаются листья, на которых развиваются небольшие красноватые пятна. На нижней их стороне виден налет, состоящий из спороношений гриба. При сильном поражении коккомикозом листья засыхают и осыпаются, снижается также качество плодов, они становятся безвкусными, водянистыми.
Возбудитель коккомикоза имеет две стадии развития. Сумчатая появляется на опавшей листве и от нее заражаются молодые листья и плоды. При благоприятных условиях, особенно в дождливое, теплое лето, болезнь быстро распространяется. От коккомикоза страдают главным образом вишни и черешни. Для борьбы с болезнью следует уничтожать опавшие листья или опрыскивать их динитрокрезолом. Эффективно трехкратное опрыскивание растений 1%-ной бордоской жидкостью: сразу после цветения, через 20 дней после первого опрыскивания, а затем после сбора урожая.
Плодовая гниль яблок
Развитию серой гнили способствует прохладная, влажная погода весной, особенно частые дожди и туманы. Поражаются все виды косточковых плодовых деревьев. Для борьбы с этой болезнью необходимо осенью или ранней весной вырезать пораженные побеги. Следует также уничтожать оставшиеся на ветках сгнившие плоды, перекапывать почву. Эффективно опрыскивание деревьев бордоской жидкостью.
Еще одна болезнь косточковых пород — коккомикоз, получила название от гриба коккомицеса. Чаще всего ею поражаются листья, на которых развиваются небольшие красноватые пятна. На нижней их стороне виден налет, состоящий из спороношений гриба. При сильном поражении коккомикозом листья засыхают и осыпаются, снижается также качество плодов, они становятся безвкусными, водянистыми.
Возбудитель коккомикоза имеет две стадии развития. Сумчатая появляется на опавшей листве и от нее заражаются молодые листья и плоды. При благоприятных условиях, особенно в дождливое, теплое лето, болезнь быстро распространяется. От коккомикоза страдают главным образом вишни и черешни. Для борьбы с болезнью следует уничтожать опавшие листья или опрыскивать их динитрокрезолом. Эффективно трехкратное опрыскивание растений 1%-ной бордоской жидкостью: сразу после цветения, через 20 дней после первого опрыскивания, а затем после сбора урожая.
Медицина и грибы
 Грибы дали человеку немало средств в борьбе с болезнями и главное из них — антибиотик
Медицина — одна из важнейших областей науки и практической деятельности человека, в которой он сталкивается с грибами. Одни из них вызывают опасные заболевания у людей и животных, другие образуют разнообразные вещества (антибиотики, алкалоиды и др.), обладающие лечебным действием. Существует даже специальный раздел медицины — медицинская микология, занимающаяся болезнями человека, вызываемыми грибами.
Грибы дали человеку немало средств в борьбе с болезнями и главное из них — антибиотик
Медицина — одна из важнейших областей науки и практической деятельности человека, в которой он сталкивается с грибами. Одни из них вызывают опасные заболевания у людей и животных, другие образуют разнообразные вещества (антибиотики, алкалоиды и др.), обладающие лечебным действием. Существует даже специальный раздел медицины — медицинская микология, занимающаяся болезнями человека, вызываемыми грибами.
Грибы — возбудители болезней человека и животных
Заболевания, вызываемые грибами, подразделяются, в зависимости от их причины, на две большие группы: • микозы, или грибные болезни, развивающиеся в результате прямого паразитизма грибов в организме человека или животных — на кожных покровах (дерматомикозы) или во внутренних органах (так называемые глубокие микозы); • микотоксикозы, или грибные отравления, связанные с образованием грибами ядов (токсинов); такие отравления вызываются употреблением в пищу продуктов или кормов, на которых развивались токсичные грибы. Среди заболеваний, причиной которых могут быть грибы или продукты их обмена, следует назвать и различные аллергические реакции. Они вызываются у некоторых людей вдыханием спор грибов, находящихся в воздухе, или употреблением в пищу вполне съедобных грибов, например осеннего опенка. Аллергенными свойствами обладают некоторые патогенные и многочисленные сапротрофные грибы, споры которых постоянно находятся в воздухе и в пыли. Известно более 300 видов грибов, вызывающих аллергические реакции. Среди них такие широко распространенные обитатели почвы и различных растительных остатков, как пенициллы, аспергиллы, альтернарии, кладоспориумы и др. Вдыхание спор таких грибов вызывает у человека с повышенной чувствительностью к ним бронхиальную астму, аллергический насморк, сенную лихорадку. Известны случаи, когда аллергические реакции вызывали образующиеся в массовых количествах споры некоторых макромицетов, например домового гриба, крупных дискомицетов и др. Врачи часто встречаются в своей практике и с аллергическими реакциями на различные продукты обмена грибов, например антибиотики и токсины. У некоторых больных наблюдается повышенная чувствительность к пенициллинам, и они вызывают у них разные формы аллергии — от кожного зуда и сыпи до смертельно опасного анафилактического шока. Люди сильно различаются как по склонности к сенсибилизации (повышению чувствительности) к аллергенам, так по типам аллергических реакций, поэтому они наблюдаются далеко не у всех, кто сталкивается с аллергенами. Микозы. Из огромного числа видов грибов только относительно немногие (около 2000) способны паразитировать на животных организмах и в организме человека. Однако среди них есть возбудители довольно распространенных, а иногда и опасных для жизни болезней. Одна из наиболее распространенных групп таких грибов — дерматофиты, обитающие на кожных покровах и вызывающие их болезни (дерматомикозы) у человека и многих животных. Такие грибы образуют ферменты, разрушающие кератин — очень прочный белок, входящий в состав волос и других кожных образований, и устойчивы к кожным выделениям. Многие дерматомикозы, например парша, известны с глубокой древности. Грибы-дерматофиты в разной степени приспособлены к паразитизму и имеют разный круг хозяев. Наиболее специализированные из них вызывают заболевания только у человека и не заражают животных. При попадании в почву такие грибы быстро погибают. Очень распространены и опасны менее специализированные виды, которые могут заражать как человека, так и животных, причем инфекция часто передается от домашних животных к человеку. Примером этого может служить возбудитель микроспории собак и кошек. Грибы этой группы паразитируют не только на домашних, но и на некоторых диких животных — полевках, мышах, землеройках и др., которые также могут оказаться источником заражения дерматомикозами. Некоторые малоспециализированные дерматофиты могут длительное время обитать или сохраняться в почве, что также повышает опасность заражения ими. Кроме дерматомикозов, грибы могут поражать различные внутренние органы, вызывая ряд заболеваний — гистоплазмоз, криптококкоз, кандидозы и др. Возбудитель гистоплазмоза — гистоплазма капсюльная обнаруживается в клетках костного мозга, селезенки, печени, легких и других органов. Эта болезнь известна во многих странах, но развивается в отдельных локальных очагах в определенных районах земного шара, преимущественно с мягким климатом — в этих районах гистоплазма выделяется из почвы и воды. Особенно часто гистоплазма встречается в экскрементах летучих мышей и птиц, которые и являются переносчиками этого опасного заболевания. В литературе описаны случаи заболевания гистоплазмозом групп спелеологов, посещавших пещеры, в которых обитают летучие мыши. Возбудителями болезней человека и теплокровных животных могут быть и некоторые широко распространенные сапротрофные грибы, обитающие обычно в почве и на различных органических субстратах, например аспергилл дымящий. Аспергилл дымящий. Его споры часто являются причиной аллергических реакций. (Микрофотография)
Часто он вызывает поражения дыхательных путей у птиц, а у человека — отомикозы, аспергиллез и эмфизему легких. Споры этого гриба и образуемый им токсин могут вызывать аллергические явления с симптомами ангины.
Более или менее специализированные грибные паразиты известны и у большинства групп наземных и многих водных животных. Существуют большие группы грибов, паразитирующие на определенных группах животных. Это энтомофторовые и лабульбениевые, часто обитающие на насекомых и реже на других представителях членистоногих (пауках, клещах).
Иногда грибы — паразиты полезных животных приносят большой ущерб народному хозяйству. Так, некоторые сапролегниевые грибы, паразитирующие на икре рыб, а при неблагоприятных условиях и на взрослых рыбах, вызывают их массовую гибель и особенно опасны в рыбоводческих прудовых хозяйствах, в водоемах со слабо аэрируемой водой. Сапролегниевые можно часто встретить и в аквариумах в тех случаях, когда температура воды в них ниже нормы, т. е. рыбы содержатся в неблагоприятных условиях.
Паразит личинок медоносной пчелы — аскосфера пчелиная вызывает у пчел заболевание, которое пчеловоды называют каменной или известковой деткой. Заражая личинки, гриб вызывает быструю их гибель и мумификацию. Мумифицированные личинки имеют серовато-белую окраску и выглядят, как известковые, откуда и произошло название болезни.
Грибы — возбудители болезней насекомых могут принести и большую пользу, если они вызывают гибель вредных насекомых — вредителей сельскохозяйственных растений и леса, переносчиков болезней человека и животных и др. Еще в прошлом веке русский биолог И. И. Мечников отмечал, что грибы могут быть использованы как средство, вызывающее гибель вредных насекомых, т. е. возможность использования биологического метода борьбы с вредными насекомыми. Сейчас в СССР и за рубежом достигнуты большие успехи в развитии биологических методов борьбы с вредителями. Наряду с насекомыми и энтомопатогенными бактериями в ней широко используются и некоторые грибы, например боверия Басси, из культуры которой готовят препарат боверин, эффективный в борьбе против колорадского жука и многих других насекомых-вредителей. Близкий к ней вид боверия тонкая поражает преимущественно жуков, в том числе майских хрущей. В садах для борьбы с калифорнийской щитовкой можно использовать препарат из гриба кониотириум, вызывающий гибель до 50% этих насекомых. Поскольку грибы поражают в первую очередь ослабленных насекомых, препараты из них обычно применяют в сочетании с инсектицидами, что значительно повышает их эффективность.
Микотоксикозы. В последние годы токсикологи все больше внимания обращают на микроскопические грибы, которые развиваясь на растениях, продуктах питания или кормах, образуют токсины, вызывающие отравления при употреблении таких продуктов или кормов в пищу.
Один из наиболее распространенных и давно известных токсичных грибов — спорынья. Это паразит многочисленных культурных и дикорастущих злаков, образующий в соцветиях пораженных растений склероции, имеющие вид рожков черно-фиолетового цвета. Склероции зимуют в почве, а весной прорастают стромами с перитециями, где образуются аскоспоры, заражающие злаки в период их цветения. В склероциях спорыньи содержатся токсичные алкалоиды, и если они при уборке урожая попадут в зерно, а затем в муку и продукты из нее, может произойти отравление, получившее название эрготизм (от "эргот" — спорынья). Эрготизм проявляется в двух формах — гангренозной ("антонов огонь") и конвульсивной ("злые корчи") и обусловлен способностью алкалоидов спорыньи вызывать сокращения гладкой мускулатуры и их действием на нервную систему.
Первые сообщения об этом токсикозе обнаружены на ассирийских клинописных табличках, относящихся к 600 г. до нашей эры. Там записано, что хлебные зерна могут содержать какой-то яд. В прошлом эрготизм был широко распространен в Европе и в период сильных вспышек уносил большое число жертв. Во французской хронике конца X в., например, описана одна из таких вспышек, во время которой погибло около 40 тыс. чел. В России эрготизм появился значительно позднее, чем в Западной Европе, и впервые упоминается в Троицкой летописи в 1408 г. В наше время эрготизм наблюдается у людей крайне редко. С повышением культуры земледелия и совершенствованием методов очистки зерна от примесей эта болезнь ушла в прошлое. Однако интерес к спорынье и в наше время не ослабевает. Это связано с широким использованием алкалоидов спорыньи в современной медицине для лечения сердечно-сосудистых, нервных и некоторых других заболеваний. Из склероциев спорыньи получены многочисленные алкалоиды — производные лизергиновой кислоты (эрготамин, эрготоксин и др.). Первый химически чистый алкалоид был выделен в 1918 г., а в 1943 г. был осуществлен химический синтез диэтиламида лизергиновой кислоты — препарата ЛСД, обладающего сильным действием на центральную нервную систему и вызывающего галлюцинации.
Для получения алкалоидов спорыньи используют культуру спорыньи на ржи на специально предназначенных для этого полях или сапротрофную культуру гриба на питательных средах.
Прогресс медицины и микологии в XX в. позволил выяснить роль и других продуктов обмена грибов, способных вызывать опасные токсикозы человека и животных. Сейчас внимание специалистов в области токсикологии, ветеринарии и микологии обращено на отравления, вызываемые грибами, развивающимися на продуктах питания и кормах. Пищевые продукты растительного и животного происхождения представляют прекрасную среду для развития многочисленных грибов — мы часто сталкиваемся с плесневением продуктов при неправильном их хранении. Растительные корма уже в природных условиях заражаются грибами, а также при хранении, особенно в неблагоприятных условиях. Развиваясь на пищевых продуктах и кормах, микроскопические грибы не только используют содержащиеся в них питательные вещества, но и выделяют микотоксины, которые могут стать причиной отравлений при использовании таких продуктов в пищу.
Аспергилл дымящий. Его споры часто являются причиной аллергических реакций. (Микрофотография)
Часто он вызывает поражения дыхательных путей у птиц, а у человека — отомикозы, аспергиллез и эмфизему легких. Споры этого гриба и образуемый им токсин могут вызывать аллергические явления с симптомами ангины.
Более или менее специализированные грибные паразиты известны и у большинства групп наземных и многих водных животных. Существуют большие группы грибов, паразитирующие на определенных группах животных. Это энтомофторовые и лабульбениевые, часто обитающие на насекомых и реже на других представителях членистоногих (пауках, клещах).
Иногда грибы — паразиты полезных животных приносят большой ущерб народному хозяйству. Так, некоторые сапролегниевые грибы, паразитирующие на икре рыб, а при неблагоприятных условиях и на взрослых рыбах, вызывают их массовую гибель и особенно опасны в рыбоводческих прудовых хозяйствах, в водоемах со слабо аэрируемой водой. Сапролегниевые можно часто встретить и в аквариумах в тех случаях, когда температура воды в них ниже нормы, т. е. рыбы содержатся в неблагоприятных условиях.
Паразит личинок медоносной пчелы — аскосфера пчелиная вызывает у пчел заболевание, которое пчеловоды называют каменной или известковой деткой. Заражая личинки, гриб вызывает быструю их гибель и мумификацию. Мумифицированные личинки имеют серовато-белую окраску и выглядят, как известковые, откуда и произошло название болезни.
Грибы — возбудители болезней насекомых могут принести и большую пользу, если они вызывают гибель вредных насекомых — вредителей сельскохозяйственных растений и леса, переносчиков болезней человека и животных и др. Еще в прошлом веке русский биолог И. И. Мечников отмечал, что грибы могут быть использованы как средство, вызывающее гибель вредных насекомых, т. е. возможность использования биологического метода борьбы с вредными насекомыми. Сейчас в СССР и за рубежом достигнуты большие успехи в развитии биологических методов борьбы с вредителями. Наряду с насекомыми и энтомопатогенными бактериями в ней широко используются и некоторые грибы, например боверия Басси, из культуры которой готовят препарат боверин, эффективный в борьбе против колорадского жука и многих других насекомых-вредителей. Близкий к ней вид боверия тонкая поражает преимущественно жуков, в том числе майских хрущей. В садах для борьбы с калифорнийской щитовкой можно использовать препарат из гриба кониотириум, вызывающий гибель до 50% этих насекомых. Поскольку грибы поражают в первую очередь ослабленных насекомых, препараты из них обычно применяют в сочетании с инсектицидами, что значительно повышает их эффективность.
Микотоксикозы. В последние годы токсикологи все больше внимания обращают на микроскопические грибы, которые развиваясь на растениях, продуктах питания или кормах, образуют токсины, вызывающие отравления при употреблении таких продуктов или кормов в пищу.
Один из наиболее распространенных и давно известных токсичных грибов — спорынья. Это паразит многочисленных культурных и дикорастущих злаков, образующий в соцветиях пораженных растений склероции, имеющие вид рожков черно-фиолетового цвета. Склероции зимуют в почве, а весной прорастают стромами с перитециями, где образуются аскоспоры, заражающие злаки в период их цветения. В склероциях спорыньи содержатся токсичные алкалоиды, и если они при уборке урожая попадут в зерно, а затем в муку и продукты из нее, может произойти отравление, получившее название эрготизм (от "эргот" — спорынья). Эрготизм проявляется в двух формах — гангренозной ("антонов огонь") и конвульсивной ("злые корчи") и обусловлен способностью алкалоидов спорыньи вызывать сокращения гладкой мускулатуры и их действием на нервную систему.
Первые сообщения об этом токсикозе обнаружены на ассирийских клинописных табличках, относящихся к 600 г. до нашей эры. Там записано, что хлебные зерна могут содержать какой-то яд. В прошлом эрготизм был широко распространен в Европе и в период сильных вспышек уносил большое число жертв. Во французской хронике конца X в., например, описана одна из таких вспышек, во время которой погибло около 40 тыс. чел. В России эрготизм появился значительно позднее, чем в Западной Европе, и впервые упоминается в Троицкой летописи в 1408 г. В наше время эрготизм наблюдается у людей крайне редко. С повышением культуры земледелия и совершенствованием методов очистки зерна от примесей эта болезнь ушла в прошлое. Однако интерес к спорынье и в наше время не ослабевает. Это связано с широким использованием алкалоидов спорыньи в современной медицине для лечения сердечно-сосудистых, нервных и некоторых других заболеваний. Из склероциев спорыньи получены многочисленные алкалоиды — производные лизергиновой кислоты (эрготамин, эрготоксин и др.). Первый химически чистый алкалоид был выделен в 1918 г., а в 1943 г. был осуществлен химический синтез диэтиламида лизергиновой кислоты — препарата ЛСД, обладающего сильным действием на центральную нервную систему и вызывающего галлюцинации.
Для получения алкалоидов спорыньи используют культуру спорыньи на ржи на специально предназначенных для этого полях или сапротрофную культуру гриба на питательных средах.
Прогресс медицины и микологии в XX в. позволил выяснить роль и других продуктов обмена грибов, способных вызывать опасные токсикозы человека и животных. Сейчас внимание специалистов в области токсикологии, ветеринарии и микологии обращено на отравления, вызываемые грибами, развивающимися на продуктах питания и кормах. Пищевые продукты растительного и животного происхождения представляют прекрасную среду для развития многочисленных грибов — мы часто сталкиваемся с плесневением продуктов при неправильном их хранении. Растительные корма уже в природных условиях заражаются грибами, а также при хранении, особенно в неблагоприятных условиях. Развиваясь на пищевых продуктах и кормах, микроскопические грибы не только используют содержащиеся в них питательные вещества, но и выделяют микотоксины, которые могут стать причиной отравлений при использовании таких продуктов в пищу.
 Спорынья на колосьях ржи
Из токсинов микроскопических грибов наиболее изучены афлатоксины, образуемые некоторыми аспергиллами — желтым, паразитическим и др. История их исследования начинается с 1960 г., когда в Великобритании вспыхнула неизвестная болезнь индюшек, вызвавшая за 3 мес гибель 100 тыс. птиц. При тщательном расследовании причин болезни оказалось, что она вызвана отравлением мукой из арахиса, ввозимого из Бразилии, а ядовитые свойства его обусловлены развитием на нем гриба аспергилла желтого, образующего токсин. Позднее было установлено, что этот токсин представляет собой смесь близких по строению веществ. Особенно интенсивно гриб развивается и образует ядовитые вещества в условиях жаркого климата. В литературе описаны многочисленные случаи отравления афлатоксинами людей. Так, в 1968 году на Яве погибли 60 человек, съевших заплесневелые продукты из арахиса. Крайне опасны даже малые дозы афлатоксинов, не вызывающие острых отравлений, так как у этих токсинов установлено канцерогенное действие — они способны вызывать развитие злокачественных опухолей печени и других органов.
Спорынья на колосьях ржи
Из токсинов микроскопических грибов наиболее изучены афлатоксины, образуемые некоторыми аспергиллами — желтым, паразитическим и др. История их исследования начинается с 1960 г., когда в Великобритании вспыхнула неизвестная болезнь индюшек, вызвавшая за 3 мес гибель 100 тыс. птиц. При тщательном расследовании причин болезни оказалось, что она вызвана отравлением мукой из арахиса, ввозимого из Бразилии, а ядовитые свойства его обусловлены развитием на нем гриба аспергилла желтого, образующего токсин. Позднее было установлено, что этот токсин представляет собой смесь близких по строению веществ. Особенно интенсивно гриб развивается и образует ядовитые вещества в условиях жаркого климата. В литературе описаны многочисленные случаи отравления афлатоксинами людей. Так, в 1968 году на Яве погибли 60 человек, съевших заплесневелые продукты из арахиса. Крайне опасны даже малые дозы афлатоксинов, не вызывающие острых отравлений, так как у этих токсинов установлено канцерогенное действие — они способны вызывать развитие злокачественных опухолей печени и других органов.
Аспергилл желтый способен вызывать опасные токсикозы человека и животных
Сейчас известно большое число микроскопических грибов, прежде всего многочисленных видов пенициллов и аспергиллов, образующих опасные токсины (охра-токсины, рубратоксины, патулин и др.). Хорошо изучена большая группа токсинов трихотеценов, образуемых видами родов фузариум, трихотециум, миротециум и др. Все эти токсины крайне разнообразны как по химическому строению, так и по действию на организм человека и животных. У многих микотоксинов в последние годы обнаружено канцерогенное и тератогенное действие — они способны вызывать образование злокачественных опухолей и, нарушая развитие эмбрионов, появление различных уродств у новорожденных детенышей (в опытах на животных). Особая опасность токсинов в том, что они не только содержатся в мицелии, но и выделяются в окружающую среду, в те части продуктов, где мицелий отсутствует. Поэтому заплесневелые продукты крайне опасно употреблять в пищу даже после того, как с них удалена плесень. Многие микотоксины могут сохраняться длительное время и не разрушаются при различных обработках продуктов. Афлатоксины и охратоксины сохраняются и в тканях животных, получавших зараженные корма (арахис, бобы, зерно), и могут даже концентрироваться в них. В Южной Африке описан случай, когда содержание охратоксина в некоторых органах свиньи превышало его содержание в корме (зараженном зерне) от 3 до 30 раз.
Среди многочисленных продуктов обмена веществ у грибов есть, однако, не только ядовитые, но и обладающие лечебным действием. Так, один их трихотеценов (трихотецин) подавляет рост многих грибов патогенных для растений и животных и используется в защите растений и в ветеринарии для лечения крупного рогатого скота и пушных зверей от дерматомикозов.
Аспергилл желтый способен вызывать опасные токсикозы человека и животных
Сейчас известно большое число микроскопических грибов, прежде всего многочисленных видов пенициллов и аспергиллов, образующих опасные токсины (охра-токсины, рубратоксины, патулин и др.). Хорошо изучена большая группа токсинов трихотеценов, образуемых видами родов фузариум, трихотециум, миротециум и др. Все эти токсины крайне разнообразны как по химическому строению, так и по действию на организм человека и животных. У многих микотоксинов в последние годы обнаружено канцерогенное и тератогенное действие — они способны вызывать образование злокачественных опухолей и, нарушая развитие эмбрионов, появление различных уродств у новорожденных детенышей (в опытах на животных). Особая опасность токсинов в том, что они не только содержатся в мицелии, но и выделяются в окружающую среду, в те части продуктов, где мицелий отсутствует. Поэтому заплесневелые продукты крайне опасно употреблять в пищу даже после того, как с них удалена плесень. Многие микотоксины могут сохраняться длительное время и не разрушаются при различных обработках продуктов. Афлатоксины и охратоксины сохраняются и в тканях животных, получавших зараженные корма (арахис, бобы, зерно), и могут даже концентрироваться в них. В Южной Африке описан случай, когда содержание охратоксина в некоторых органах свиньи превышало его содержание в корме (зараженном зерне) от 3 до 30 раз.
Среди многочисленных продуктов обмена веществ у грибов есть, однако, не только ядовитые, но и обладающие лечебным действием. Так, один их трихотеценов (трихотецин) подавляет рост многих грибов патогенных для растений и животных и используется в защите растений и в ветеринарии для лечения крупного рогатого скота и пушных зверей от дерматомикозов.
Антибиотики грибов
Наиболее широко продукты обмена грибов стали использоваться в медицинской практике в наше время, справедливо названное известным американским микробиологом 3. Я. Ваксманом эрой антибиотиков. Антибиотики это вещества, образуемые различными группами живых организмов — бактериями, актиномицетами, грибами, растениями и животными и подавляющие рост других организмов. Важнейшее их свойство -избирательность действия: они действуют на одни организмы и безвредны для других. Избирательность связана с тем, что разные группы организмов различаются как по характеру своих структурных компонентов, так и по особенностям обмена. Сейчас получены многочисленные препараты, которые подавляют рост болезнетворных микробов, но не токсичны для человека и животных, — пенициллин, цефалоспорин, стрептомицин, тетрациклин и др. Первый антибиотик, нашедший широкое применение в медицинской практике, — пенициллин был обнаружен английским микробиологом А. Флемингом в 1928 г. в культуре микроскопического гриба пенициллиума нотатум. Однако еще задолго до этого пенициллы (зеленая плесень) привлекали внимание врачей лечебными свойствами. В рукописях XVII в. есть сведения, что майя пользовались ею для лечения ран. Великий врач, философ и естествоиспытатель Авиценна в своем многотомном труде "Каноне врачебной науки" (начало XI в.) упоминает о лечебном действии зеленой плесени при гнойных заболеваниях. Первые научные исследования воздействия микроскопических грибов на бактерии были проведены во второй половине XIX в. В 1871 и 1872 гг. русские врачи В. А. Манассеин и А. Г. Полотебнов опубликовали свои сообщения о действии пеницилла на бактерии и результатах лечения им гнойных ран. Годом позднее английский ученый У. Робертс обнаружил, что в жидких средах, на которых он выращивал один из пенициллов, бактерии росли плохо. На основании своих наблюдений он сделал вывод о существовании антагонизма между грибами и бактериями. В конце прошлого века был получен из грибов и первый антибиотик — микофеноловая кислота, оказавшаяся токсичной и не нашедшая поэтому практического применения. Сообщения об антагонистических свойствах бактерий и актиномицетов появились позднее, в 1877 и 1890 гг. Таким образом, микроскопические грибы были первой группой микроорганизмов, у которой было обнаружено антагонистическое действие на бактерии и был получен первый в истории антибиотик. К концу 20-х годов нашего века микробиологией был накоплен большой материал о влиянии различных микроорганизмов на бактерии. Поэтому открытие, сделанное А. Флемингом в 1928 г., не было случайностью. Оно было подготовлено и его собственными исследованиями лизоцима (фермента, обнаруженного в слезах, слюне, яичном белке и др.), вызывающего гибель различных бактерий, в том числе и болезнетворных. В 1928 г., работая с патогенными стафилококками в бактериологической лаборатории одной из больниц Лондона, он обнаружил в одной из чашек с культурами этих бактерий колонию плесневого гриба, попавшего в нее из воздуха. Колонии стафилококков вокруг этой колонии постепенно становились все более прозрачными и исчезали. А. Флеминг заинтересовался этим грибом: выделил его в чистую культуру, вырастил на мясном бульоне и изучил действие фильтрата культуры на бактерии. Оказалось, что этот фильтрат сильно подавляет рост бактерий и не токсичен для животных. Выделенный гриб был определен А. Флемингом как пенициллиум нотатум, а активный фильтрат его культуры получил название пенициллина. Сообщение об открытии А. Флеминга было опубликовано в 1929 г., однако все попытки выделить активное вещество из культуральной жидкости долгое время терпели неудачу. И только в 1940 г. группе исследователей из Оксфорда — Г. У. Флори, Э. Б. Чейну и др. — удалось получить стабильный препарат пенициллина и провести его испытания в опытах на животных. В начале 1941 г. препарат был впервые испытан в клинике. За короткий период был значительно усовершенствован метод выращивания продуцента: разработаны новые, дешевые и эффективные питательные среды, содержащие кукурузный экстракт (отход при производстве кукурузного крахмала, содержащий вещества, стимулирующие биосинтез пенициллина), а главное, метод глубинного культивирования гриба в ферментерах при постоянном перемешивании и притоке стерильного воздуха. В 1944 г. в производство был введен новый продуцент пенициллина — пенициллиум хризогенум, который используется и сейчас. Конидиеносец пеницилла. Этот гриб используется сейчас для промышленного производства пенициллина
В СССР исследования пенициллина проводила 3. В. Ермольева "во Всесоюзном институте экспериментальной медицины в Москве. В годы Великой Отечественной войны страна остро нуждалась в препарате для лечения раненых. Уже в 1942 г. группе под руководством 3. В. Ермольевой удалось получить такой препарат — пенициллин крустозин, а в 1943 г. было налажено его промышленное производство.
Исследованиями было установлено, что пенициллиум гризогенум образует не один антибиотик, а целую группу веществ близких по химическому строению, в дальнейшем оказалось возможным создать новые варианты антибиотика. Сейчас получено много полусинтетических пенициллинов с ценными для медицины свойствами. Ученым удалось получить и такие полусинтетические пенициллины, которые отличаются от природных и по спектру своего антибактериального действия. Наиболее известный из них — ампициллин действует на многие бактерии, устойчивые к другим пенициллинам.
В начале 40-х годов, сразу же после внедрения пенициллина в медицинскую практику, в лабораториях многих стран мира развернулись интенсивные поиски новых антибиотиков. За короткое время были открыты такие антибиотики, как стрептомицин, действующий на возбудителя туберкулеза, тетрациклины и хлоромицетин — препараты широкого антибактериального действия, нистатин, действующий на грибы, и др. Начиная с 50-х годов начались поиски препаратов для лечения злокачественных опухолей. Сейчас получено более 500 антибиотиков грибного происхождения. В медицине или в сельском хозяйстве используется достаточно широко не более 10 препаратов, образуемых микромицетами. Это антибактериальные антибиотики цефалоспорины и фузидин, противогрибные антибиотики гризеофульвин (эффективный при лечении дерматомикозов), трихотецин (используемый для защиты растений от грибных болезней и лечения дерматомикозов у животных), фумагиллин (применяется в медицине для лечения амебной дизентерии, а в сельском хозяйстве для лечения пчел от нозематоза).
Ряд интересных и, возможно, перспективных для практики препаратов получен из макромицетов. Этой группой грибов исследователи начали заниматься давно. Еще в 1923 г. из культуры грибной капусты был получен антибиотик спарассол, действующий на некоторые грибы и близкий к продукту обмена лишайников — эверниновой кислоте. В 1940-1950 гг. в лабораториях Англии, США и других стран было исследовано действие на бактерии и грибы экстрактов из плодовых тел и культур более 2000 видов макромицетов — трутовиков, шляпочных грибов и др. Поиски антибиотиков этой группы грибов продолжаются.
Конидиеносец пеницилла. Этот гриб используется сейчас для промышленного производства пенициллина
В СССР исследования пенициллина проводила 3. В. Ермольева "во Всесоюзном институте экспериментальной медицины в Москве. В годы Великой Отечественной войны страна остро нуждалась в препарате для лечения раненых. Уже в 1942 г. группе под руководством 3. В. Ермольевой удалось получить такой препарат — пенициллин крустозин, а в 1943 г. было налажено его промышленное производство.
Исследованиями было установлено, что пенициллиум гризогенум образует не один антибиотик, а целую группу веществ близких по химическому строению, в дальнейшем оказалось возможным создать новые варианты антибиотика. Сейчас получено много полусинтетических пенициллинов с ценными для медицины свойствами. Ученым удалось получить и такие полусинтетические пенициллины, которые отличаются от природных и по спектру своего антибактериального действия. Наиболее известный из них — ампициллин действует на многие бактерии, устойчивые к другим пенициллинам.
В начале 40-х годов, сразу же после внедрения пенициллина в медицинскую практику, в лабораториях многих стран мира развернулись интенсивные поиски новых антибиотиков. За короткое время были открыты такие антибиотики, как стрептомицин, действующий на возбудителя туберкулеза, тетрациклины и хлоромицетин — препараты широкого антибактериального действия, нистатин, действующий на грибы, и др. Начиная с 50-х годов начались поиски препаратов для лечения злокачественных опухолей. Сейчас получено более 500 антибиотиков грибного происхождения. В медицине или в сельском хозяйстве используется достаточно широко не более 10 препаратов, образуемых микромицетами. Это антибактериальные антибиотики цефалоспорины и фузидин, противогрибные антибиотики гризеофульвин (эффективный при лечении дерматомикозов), трихотецин (используемый для защиты растений от грибных болезней и лечения дерматомикозов у животных), фумагиллин (применяется в медицине для лечения амебной дизентерии, а в сельском хозяйстве для лечения пчел от нозематоза).
Ряд интересных и, возможно, перспективных для практики препаратов получен из макромицетов. Этой группой грибов исследователи начали заниматься давно. Еще в 1923 г. из культуры грибной капусты был получен антибиотик спарассол, действующий на некоторые грибы и близкий к продукту обмена лишайников — эверниновой кислоте. В 1940-1950 гг. в лабораториях Англии, США и других стран было исследовано действие на бактерии и грибы экстрактов из плодовых тел и культур более 2000 видов макромицетов — трутовиков, шляпочных грибов и др. Поиски антибиотиков этой группы грибов продолжаются.
 Лиственничная губка
Антибиотики известны сейчас у многих широко распространенных и широко известных шляпочных грибов и трутовиков. Уже несколько десятилетий известны антибактериальные свойства шампиньонов. В 1975 г. из плодовых тел шампиньона обыкновенного был получен антибиотик агаридоксин, обладающий сильно выраженным действием на некоторые бактерии, в том числе и болезнетворные. Антибиотик небулярин, полученный в 1954 г. из плодовых тел серой говорушки, подавляет рост микобактерий и действует на некоторые опухоли у лабораторных животных, однако он высокотоксичен. Антибиотик лактаровиолин, полученный из рыжика, действует на многие бактерии, в том числе и на возбудителя туберкулеза. Можно также назвать стробилурины, образуемые стробилурусом прочным — одним из самых ранних весенних шляпочных грибов — и подавляющие рост некоторых микроскопических грибов. Такие часто встречающиеся древоразрушающие грибы, как заборный гриб и березовая губка, также образуют антибиотики: первый действует на грибы, а второй подавляет рост некоторых микобактерий.
Лиственничная губка
Антибиотики известны сейчас у многих широко распространенных и широко известных шляпочных грибов и трутовиков. Уже несколько десятилетий известны антибактериальные свойства шампиньонов. В 1975 г. из плодовых тел шампиньона обыкновенного был получен антибиотик агаридоксин, обладающий сильно выраженным действием на некоторые бактерии, в том числе и болезнетворные. Антибиотик небулярин, полученный в 1954 г. из плодовых тел серой говорушки, подавляет рост микобактерий и действует на некоторые опухоли у лабораторных животных, однако он высокотоксичен. Антибиотик лактаровиолин, полученный из рыжика, действует на многие бактерии, в том числе и на возбудителя туберкулеза. Можно также назвать стробилурины, образуемые стробилурусом прочным — одним из самых ранних весенних шляпочных грибов — и подавляющие рост некоторых микроскопических грибов. Такие часто встречающиеся древоразрушающие грибы, как заборный гриб и березовая губка, также образуют антибиотики: первый действует на грибы, а второй подавляет рост некоторых микобактерий.
 Рисунок из рукописного русского травника XVII в. Лиственничкая губка, изображенная здесь, упоминается как лечебное средство в трудах ученых и врачей древности: Плиния, Диоскорида, Галена и др. Еще в начале нашего века она занимала заметное место в фармокологии. Сейчас этот гриб используется в медицине редко
С 60-х годов ведутся поиски противоопухолевых антибиотиков из макромицетов. Уже получены такие соединения, как кальвацин, образуемый лангерманнией гигантской и некоторыми видами головачей. Это вещество содержится в плодовых телах грибов (правда, в очень небольших количествах) и образуется при их росте в культуре на питательных средах. Кальвацин подавляет развитие некоторых злокачественных опухолей. Кальвациевая кислота, образуемая некоторыми видами головачей (лиловым и др.), а также широко распространенным и хорошо всем известным дождевиком грушевидным, подавляет развитие многих бактерий и грибов, и тоже обладает противоопухолевым действием. Возможно, именно присутствием этого вещества и объясняется лечебное действие некоторых дождевиков и головачей при поранениях. Путем химического синтеза получены многочисленные производные кальвациевой кислоты, также обладающие антибиотическими свойствами.
Рисунок из рукописного русского травника XVII в. Лиственничкая губка, изображенная здесь, упоминается как лечебное средство в трудах ученых и врачей древности: Плиния, Диоскорида, Галена и др. Еще в начале нашего века она занимала заметное место в фармокологии. Сейчас этот гриб используется в медицине редко
С 60-х годов ведутся поиски противоопухолевых антибиотиков из макромицетов. Уже получены такие соединения, как кальвацин, образуемый лангерманнией гигантской и некоторыми видами головачей. Это вещество содержится в плодовых телах грибов (правда, в очень небольших количествах) и образуется при их росте в культуре на питательных средах. Кальвацин подавляет развитие некоторых злокачественных опухолей. Кальвациевая кислота, образуемая некоторыми видами головачей (лиловым и др.), а также широко распространенным и хорошо всем известным дождевиком грушевидным, подавляет развитие многих бактерий и грибов, и тоже обладает противоопухолевым действием. Возможно, именно присутствием этого вещества и объясняется лечебное действие некоторых дождевиков и головачей при поранениях. Путем химического синтеза получены многочисленные производные кальвациевой кислоты, также обладающие антибиотическими свойствами.
 Говорушка серая, из которой получен антибиотик небулярин
Эти примеры показывают, что возможности грибов как продуцентов антибиотиков еще далеко не исчерпаны, и недаром многочисленные исследовательские лаборатории в наши дни вновь ведут поиски новых биологически активных веществ у грибов самых разных групп.
Говорушка серая, из которой получен антибиотик небулярин
Эти примеры показывают, что возможности грибов как продуцентов антибиотиков еще далеко не исчерпаны, и недаром многочисленные исследовательские лаборатории в наши дни вновь ведут поиски новых биологически активных веществ у грибов самых разных групп.
 Чагу нередко можно встретить в наших лесах на стволах живых берез. Популярность этого гриба в народной медицине привлекла к нему внимание ученых, обнаружевших в нем соединения, обладающие высокой физиологической активностью. В нашей стране выпускается сейчас препарат чаги — бефунгин
Говоря о применении продуктов обмена грибов в медицине, нельзя не упомянуть и вещества с психотропным действием — псилоцибин и псилоцин. Они обнаружены у более чем 300 видов шляпочных грибов из родов псилоцибе, строфария и др. Эти вещества в сильной степени влияют на деятельность центральной нервной системы и обладают галлюциногенным действием. Псилоцибин используется для лечения некоторых психических заболеваний, для восстановления памяти у больных и в других случаях.
Чагу нередко можно встретить в наших лесах на стволах живых берез. Популярность этого гриба в народной медицине привлекла к нему внимание ученых, обнаружевших в нем соединения, обладающие высокой физиологической активностью. В нашей стране выпускается сейчас препарат чаги — бефунгин
Говоря о применении продуктов обмена грибов в медицине, нельзя не упомянуть и вещества с психотропным действием — псилоцибин и псилоцин. Они обнаружены у более чем 300 видов шляпочных грибов из родов псилоцибе, строфария и др. Эти вещества в сильной степени влияют на деятельность центральной нервной системы и обладают галлюциногенным действием. Псилоцибин используется для лечения некоторых психических заболеваний, для восстановления памяти у больных и в других случаях.
Ядовитые грибы
 Ядовитость грибов человек установил собственным горьким опытом
Ядовитость грибов человек установил собственным горьким опытом
Грибы несъедобные, условно съедобные и ядовитые
На территории Европы встречается около 80 видов (по другим данным, до 100) грибов, употребление которых в пищу всегда или при определенных условиях может вызвать неприятные явления или серьезные нарушения функций организма, вплоть до опасных для жизни. Эти грибы подразделяются на три большие группы: несъедобные, условно съедобные и ядовитые. К несъедобным относят такие грибы, которые не содержат ядовитых веществ, но имеют неприятный запах (например, карболки) или чаще горький или едкий вкус. Эти грибы не вызывают отравлений, но могут быть причиной неприятных ощущений или легких нарушений пищеварения, причем часто один такой гриб, попав в массу съедобных грибов, способен испортить приготовленное из них блюдо. Один из наиболее распространенных и часто по ошибке собираемых малоопытными грибниками несъедобных грибов — горчак, или желчный гриб. Он часто встречается в хвойных лесах на почве у основания стволов и пней и на первый взгляд действительно похож на некоторые формы белого гриба. Однако если рассмотреть горчак внимательно, видно, что он отличается от белого гриба черной или бурой сетчатостью на ножке, розовой или грязно-розовой раской трубчатого слоя в зрелом возрасте и слегка розовеющей на изломе мякотью. Отличается он от белого гриба и очень горьким вкусом мякоти, за что и получил свое название. Среди трубчатых шляпочных грибов есть и другие несъедобные виды. В сухих хвойных лесах; особенно сосновых, часто встречается перечный гриб — близкий родственник маслят. От большинства из них он отличается тем, что имеет красновато-коричневый или ржаво-коричневый трубчатый слой и слегка краснеющую на изломе мякоть с острым перечным вкусом. Следует упомянуть и довольно распространенную чешуйчатку обыкновенную, образующую на живых стволах и валежнике лиственных деревьев большие группы плодовых тел, иногда принимаемую за группу опенков. Она отличается от последних желтовато-бурой или охряной сильно чешуйчатой шляпкой и буроватой мякотью с очень характерным запахом и вкусом. К несъедобным грибам принадлежат некоторые млечники (серо-розовый, шиповатый и др.), сыроежки (пятнистая, темно-фиолетовая, рвотная и др.), отличающиеся острым жгуче-едким вкусом мякоти. Рвотную сыроежку, часто растущую в лиственных и сосновых лесах южных районов, например на Украине, легко можно спутать с другими видами, имеющими красную окраску шляпки. Условно съедобными называют грибы, содержащие ядовитые или сильно раздражающие вещества, которые, однако, разрушаются или удаляются при соответствующей обработке грибов. Такие грибы пригодны в пищу после предварительного отваривания, реже вымачивания, сушки или засолки. Горчак, или желчный гриб, в молодом возрасте похож на белый гриб
Условно съедобные грибы появляются в наших лесах ранней весной — это сморчки и строчки. В микологической литературе издавна существовало мнение, что в этих грибах содержится гельвелловая кислота, которая удаляется из них при отваривании в течение 15-20 мин и последующей тщательной промывки водой. Относительно недавно было установлено, что гельвелловой кислоты не существует, а строчки содержат токсины из группы гидразинов, которые более подробно мы рассмотрим далее. При указанной выше обработке грибов эти токсины удаляются полностью или частично, и после этого грибы можно употреблять в пищу. Токсины можно удалить, высушивая грибы.
Горчак, или желчный гриб, в молодом возрасте похож на белый гриб
Условно съедобные грибы появляются в наших лесах ранней весной — это сморчки и строчки. В микологической литературе издавна существовало мнение, что в этих грибах содержится гельвелловая кислота, которая удаляется из них при отваривании в течение 15-20 мин и последующей тщательной промывки водой. Относительно недавно было установлено, что гельвелловой кислоты не существует, а строчки содержат токсины из группы гидразинов, которые более подробно мы рассмотрим далее. При указанной выше обработке грибов эти токсины удаляются полностью или частично, и после этого грибы можно употреблять в пищу. Токсины можно удалить, высушивая грибы.
 Свинушку, считавшуюся ранее условно съедовной, следует условно отнести к разряду ядовитых грибов. По последним данным, употредление ее в пищу вызывает сильное отравление, иногда и смертельное
Употребление необработанных строчков в пищу опасно, так как может вызвать серьезные отравления. По мнению экспертов, около 1 млн. чел. в год ест эти грибы, поэтому описанные случаи отравления ими относительно немногочисленны, однако в некоторых странах на долю строчков приходится заметная часть отравлений со смертельным исходом. Например, из 64 случаев смертельного отравления грибами, описанных в США в 1931-1968 гг., 7 были вызваны строчками, а в странах Европы грибы этой группы вызывают 2-4% всех отравлений грибами. Поэтому совершенно очевидно, что нужна большая осторожность и тщательная обработка при употреблении этих грибов в пищу.
Свинушку, считавшуюся ранее условно съедовной, следует условно отнести к разряду ядовитых грибов. По последним данным, употредление ее в пищу вызывает сильное отравление, иногда и смертельное
Употребление необработанных строчков в пищу опасно, так как может вызвать серьезные отравления. По мнению экспертов, около 1 млн. чел. в год ест эти грибы, поэтому описанные случаи отравления ими относительно немногочисленны, однако в некоторых странах на долю строчков приходится заметная часть отравлений со смертельным исходом. Например, из 64 случаев смертельного отравления грибами, описанных в США в 1931-1968 гг., 7 были вызваны строчками, а в странах Европы грибы этой группы вызывают 2-4% всех отравлений грибами. Поэтому совершенно очевидно, что нужна большая осторожность и тщательная обработка при употреблении этих грибов в пищу.
 Несъедобная чешуйчатка обыкновенная
К условно съедобным грибам принадлежат также многочисленные млечники и некоторые сыроежки, имеющие жгучий или горький вкус (скрипица, перечный груздь, волнушки, черный груздь и многие другие) или неприятный запах (валуй). Из-за этого их можно использовать в пищу преимущественно для засола и только после . предварительного отваривания. Некоторые из грибов (валуй, скрипицу) необходимо предварительно долго вымачивать, многократно сменяя воду. Рекомендуется отваривать перед приготовлением и свинушки толстую и тонкую. Однако надо заметить, что в последние годы появилось много случаев отравления свинушкой тонкой. Так, в Польше в Познаньском воеводстве за период 1961-1970 гг. из 857 случаев отравления грибами более 30% были вызваны этим грибом. Случаи отравления свинушкой тонкой зарегистрированы и в ряде других европейских стран. Поэтому сейчас ее нужно совсем исключить из числа съедобных грибов, тем более если учесть, что токсические вещества этого гриба накапливаются в организме постепенно, и симптомы отравления проявляются только после многократного употребления его в пищу.
В группу ядовитых объединяют грибы, в плодовых телах которых на всех стадиях их развития содержатся ядовитые вещества — токсины, вызывающие отравления. В Европе к наиболее опасным относят около20-25 видов, среди них смертельно ядовитые грибы — бледная поганка, мухоморы вонючий и весенний, некоторые волоконницы, особенно волоконница Патуйяра, паутинник оранжево-красный, мухоморы красный, пантерный и Виттадини, некоторые виды грибов-зонтиков (буровато-красноватый и бледно-розовый), говорушек (беловатая, восковатая и др.), рядовок (тигровая, белая, серно-желтая и др.), шампиньоны желтокожий и пестрый, многие энтоломы (серая, желтовато-сизая и др.) и др. Отравления вызывают также ложные опенки — серно-желтый и кирпично-красный, ложная лисичка и сатанинский гриб, однако последие два вида некоторые авторы считают несъедобными или даже условно съедобными грибами. Есть сведения об отравлении, вызванном в Чехословакии миценой чистой.
Несъедобная чешуйчатка обыкновенная
К условно съедобным грибам принадлежат также многочисленные млечники и некоторые сыроежки, имеющие жгучий или горький вкус (скрипица, перечный груздь, волнушки, черный груздь и многие другие) или неприятный запах (валуй). Из-за этого их можно использовать в пищу преимущественно для засола и только после . предварительного отваривания. Некоторые из грибов (валуй, скрипицу) необходимо предварительно долго вымачивать, многократно сменяя воду. Рекомендуется отваривать перед приготовлением и свинушки толстую и тонкую. Однако надо заметить, что в последние годы появилось много случаев отравления свинушкой тонкой. Так, в Польше в Познаньском воеводстве за период 1961-1970 гг. из 857 случаев отравления грибами более 30% были вызваны этим грибом. Случаи отравления свинушкой тонкой зарегистрированы и в ряде других европейских стран. Поэтому сейчас ее нужно совсем исключить из числа съедобных грибов, тем более если учесть, что токсические вещества этого гриба накапливаются в организме постепенно, и симптомы отравления проявляются только после многократного употребления его в пищу.
В группу ядовитых объединяют грибы, в плодовых телах которых на всех стадиях их развития содержатся ядовитые вещества — токсины, вызывающие отравления. В Европе к наиболее опасным относят около20-25 видов, среди них смертельно ядовитые грибы — бледная поганка, мухоморы вонючий и весенний, некоторые волоконницы, особенно волоконница Патуйяра, паутинник оранжево-красный, мухоморы красный, пантерный и Виттадини, некоторые виды грибов-зонтиков (буровато-красноватый и бледно-розовый), говорушек (беловатая, восковатая и др.), рядовок (тигровая, белая, серно-желтая и др.), шампиньоны желтокожий и пестрый, многие энтоломы (серая, желтовато-сизая и др.) и др. Отравления вызывают также ложные опенки — серно-желтый и кирпично-красный, ложная лисичка и сатанинский гриб, однако последие два вида некоторые авторы считают несъедобными или даже условно съедобными грибами. Есть сведения об отравлении, вызванном в Чехословакии миценой чистой.
 1 — волоконница Патуйяра; 2 — зонтик гребенчатый; 3 — шампиньон желтокожий
Встречаются также съедобные грибы, которые при определенных условиях могут вызвать отравления. Это — навозники белый, серый и др. Их можно есть в отваренном или жареном видах, но ни в коем случае нельзя употреблять вместе со спиртными напитками. В этих грибах содержится токсин, который не растворяется в воде при их приготовлении и в обычных условиях не всасывается в кишечнике, однако он легко растворяется в спирте и при употреблении напитков даже с относительно низким его содержанием быстро всасывается, попадает в кровь и уже через час вызывает характерные симптомы отравления, сохраняющиеся в течение нескольких часов. У больного учащается пульс, появляется ощущение жара и сильной жажды, лицо, а часто и другие части тела становятся фиолетово-красными, наступает расстройство пищеварения, проявляющееся в рвоте и поносе.
1 — волоконница Патуйяра; 2 — зонтик гребенчатый; 3 — шампиньон желтокожий
Встречаются также съедобные грибы, которые при определенных условиях могут вызвать отравления. Это — навозники белый, серый и др. Их можно есть в отваренном или жареном видах, но ни в коем случае нельзя употреблять вместе со спиртными напитками. В этих грибах содержится токсин, который не растворяется в воде при их приготовлении и в обычных условиях не всасывается в кишечнике, однако он легко растворяется в спирте и при употреблении напитков даже с относительно низким его содержанием быстро всасывается, попадает в кровь и уже через час вызывает характерные симптомы отравления, сохраняющиеся в течение нескольких часов. У больного учащается пульс, появляется ощущение жара и сильной жажды, лицо, а часто и другие части тела становятся фиолетово-красными, наступает расстройство пищеварения, проявляющееся в рвоте и поносе.
 Навозники серый и белый ядовиты лишь при определенных условиях
Тяжелое отравление может вызвать и употребление в пищу хорошо известных съедобных грибов (белых и др.), если они собраны переросшими, червивыми, уже начавшими разлагаться, или начали портиться при транспортировке и хранении. В таких случаях в их тканях образуются токсичные продукты разложения белков, подобные тем, которые присутствуют в испорченных рыбных или мясных продуктах. Очень опасны отравления, вызываемые грибными консервами в банках с закатанными крышками, приготовленными в домашних условиях, часто без соблюдения необходимых правил гигиены и режима стерилизации. Особенно часты они при консервировании этим способом жареных грибов. В герметически закрытых банках развиваются анаэробные бактерии, образующие токсины, в ничтожных концентрациях вызывающие сильные отравления, например клостридиум, токсин которого вызывает очень тяжелое отравление — ботулизм. Эти бактерии образуют очень устойчивые к термической обработке споры и нередко развиваются также на мясных и овощных консервах домашнего приготовления при плохой их стерилизации.
Навозники серый и белый ядовиты лишь при определенных условиях
Тяжелое отравление может вызвать и употребление в пищу хорошо известных съедобных грибов (белых и др.), если они собраны переросшими, червивыми, уже начавшими разлагаться, или начали портиться при транспортировке и хранении. В таких случаях в их тканях образуются токсичные продукты разложения белков, подобные тем, которые присутствуют в испорченных рыбных или мясных продуктах. Очень опасны отравления, вызываемые грибными консервами в банках с закатанными крышками, приготовленными в домашних условиях, часто без соблюдения необходимых правил гигиены и режима стерилизации. Особенно часты они при консервировании этим способом жареных грибов. В герметически закрытых банках развиваются анаэробные бактерии, образующие токсины, в ничтожных концентрациях вызывающие сильные отравления, например клостридиум, токсин которого вызывает очень тяжелое отравление — ботулизм. Эти бактерии образуют очень устойчивые к термической обработке споры и нередко развиваются также на мясных и овощных консервах домашнего приготовления при плохой их стерилизации.
 Навозники серый и белый ядовиты лишь при определенных условиях
Навозники серый и белый ядовиты лишь при определенных условиях
Грибы-двойники
Часто ядовитые грибы бывают похожи на широко распространенные съедобные грибы, и неопытный грибник может их легко спутать. В одних случаях это сходство довольно поверхностно, а в других настолько сильно, что при определении грибов ошибиться может даже сборщик с большим стажем. Такие грибы называют грибами-двойниками. Известно много их видов, причем особенно опасно, что двойники есть у многих смертельно ядовитых грибов. Это и приводит нередко к роковым ошибкам при сборе грибов, служит одной из наиболее частых причин грибных отравлений. Ниже приводится краткая характеристика некоторых часто встречающихся грибов-двойников, а также ряда опасных ядовитых грибов. Мухомор поганковидный хотя и не так ядовит, как бледная поганка, но все же вызывает серьезные отравления
Наиболее опасна, смертельно ядовита бледная поганка. Она встречается преимущественно в лиственных или смешанных лесах под дубами, липой, кленом, орешником и другими широколиственными породами на хорошо освещенных местах, часто в августе, иногда до конца сентября. Это очень красивый гриб с оливково-зеленой, обычно к центру более темной, шелковистой, а иногда радиально волокнистой шляпкой. Остатки покрывала на ней обычно не сохраняются, пластинки и споровый порошок, как и у других мухоморов, белые. Ножка белая, часто с зеленоватым муаровым рисунком и хорошо выраженным долго сохраняющимся кольцом.
Мухомор поганковидный хотя и не так ядовит, как бледная поганка, но все же вызывает серьезные отравления
Наиболее опасна, смертельно ядовита бледная поганка. Она встречается преимущественно в лиственных или смешанных лесах под дубами, липой, кленом, орешником и другими широколиственными породами на хорошо освещенных местах, часто в августе, иногда до конца сентября. Это очень красивый гриб с оливково-зеленой, обычно к центру более темной, шелковистой, а иногда радиально волокнистой шляпкой. Остатки покрывала на ней обычно не сохраняются, пластинки и споровый порошок, как и у других мухоморов, белые. Ножка белая, часто с зеленоватым муаровым рисунком и хорошо выраженным долго сохраняющимся кольцом.
 Бледная поганка. Отличить ее от сыроежек с зеленым цветом шляпки можно по хорошо заметной свободной мешковидной вольве, кольцу и муаровому рисунку на ножке
У основания хорошо заметна вольва — остаток общего покрывала, одевающего в молодом возрасте все плодовое тело гриба, она белая, свободная, разорванная на лопасти. По характеру образуемых токсинов и симптомам отравления к бледной поганке близки и два других смертельно ядовитых гриба — мухоморы белый, или весенний, и вонючий.
Бледная поганка. Отличить ее от сыроежек с зеленым цветом шляпки можно по хорошо заметной свободной мешковидной вольве, кольцу и муаровому рисунку на ножке
У основания хорошо заметна вольва — остаток общего покрывала, одевающего в молодом возрасте все плодовое тело гриба, она белая, свободная, разорванная на лопасти. По характеру образуемых токсинов и симптомам отравления к бледной поганке близки и два других смертельно ядовитых гриба — мухоморы белый, или весенний, и вонючий.
 Бледная поганка. Отличить ее от сыроежек с зеленым цветом шляпки можно по хорошо заметной свободной мешковидной вольве, кольцу и муаровому рисунку на ножке
Вонючий мухомор по внешнему виду мало похож на бледную поганку, хотя и сходен с ней строением плодового тела. Его шляпка не превышает в диаметре 7 см, полушаровидной или конической формы с характерным бугорком или заостренной верхушкой, в сухом состоянии блестящая. Гриб имеет белую окраску, лишь у старых экземпляров шляпка слабо-желтоватая. Ножка белая, лохматая, с кольцом, часто плохо различимым из-за хлопьев на ножке. Вольва свободная, мешковидная, белого цвета.
Бледная поганка. Отличить ее от сыроежек с зеленым цветом шляпки можно по хорошо заметной свободной мешковидной вольве, кольцу и муаровому рисунку на ножке
Вонючий мухомор по внешнему виду мало похож на бледную поганку, хотя и сходен с ней строением плодового тела. Его шляпка не превышает в диаметре 7 см, полушаровидной или конической формы с характерным бугорком или заостренной верхушкой, в сухом состоянии блестящая. Гриб имеет белую окраску, лишь у старых экземпляров шляпка слабо-желтоватая. Ножка белая, лохматая, с кольцом, часто плохо различимым из-за хлопьев на ножке. Вольва свободная, мешковидная, белого цвета.
 Такие же смертельно ядовитые грибы, как и бледная поганка, — мухоморы весенний(вверху) и вонючий, встречающийся значительно чаще. Оба гриба чисто-белого цвета, отличаются лишь размерами и строением ножки: у мухомора вонючего она покрыта хлопьями, а у весеннего гладкая
Развивается этот гриб в те же сроки, что и бледная поганка, но в отличие от нее встречается в основном в хвойных (еловых и сосновых) лесах преимущественно северных и северо-западных районов нашей страны, а также в пихтово-сосновых лесах Дальнего Востока.
Такие же смертельно ядовитые грибы, как и бледная поганка, — мухоморы весенний(вверху) и вонючий, встречающийся значительно чаще. Оба гриба чисто-белого цвета, отличаются лишь размерами и строением ножки: у мухомора вонючего она покрыта хлопьями, а у весеннего гладкая
Развивается этот гриб в те же сроки, что и бледная поганка, но в отличие от нее встречается в основном в хвойных (еловых и сосновых) лесах преимущественно северных и северо-западных районов нашей страны, а также в пихтово-сосновых лесах Дальнего Востока.
 Такие же смертельно ядовитые грибы, как и бледная поганка, — мухоморы весенний(вверху) и вонючий, встречающийся значительно чаще. Оба гриба чисто-белого цвета, отличаются лишь размерами и строением ножки: у мухомора вонючего она покрыта хлопьями, а у весеннего гладкая
Мухомор весенний тоже имеет белую окраску и встречается в лиственных и смешанных лесах в июне и до осени в более южных районах. Плодовые тела его меньшего размера, шляпка без бугорка, колокольчатая, ножка гладкая, без хлопьев, с хорошо выраженным кольцом. У трех описанных наиболее опасных видов ядовитых грибов, вызывающих, по некоторым данным, до 90% всех смертельных случаев отравления грибами, имеется много съедобных двойников, что повышает вероятность их ошибочного сбора. Обычно наиболее похожими на эти виды считают шампиньоны лесной и полевой, однако при более внимательном взгляде их отличить довольно легко. Шампиньоны, правда, окраской шляпки и кольцом на ножке похожи на мухоморы вонючий и весенний и даже на более светлоокрашенные экземпляры бледной поганки, но отличаются отсутствием вольвы у основания ножки. Поэтому очень важно срывать шампиньон с ножкой, чтобы убедиться в отсутствии вольвы, а не срезать шляпки.
Такие же смертельно ядовитые грибы, как и бледная поганка, — мухоморы весенний(вверху) и вонючий, встречающийся значительно чаще. Оба гриба чисто-белого цвета, отличаются лишь размерами и строением ножки: у мухомора вонючего она покрыта хлопьями, а у весеннего гладкая
Мухомор весенний тоже имеет белую окраску и встречается в лиственных и смешанных лесах в июне и до осени в более южных районах. Плодовые тела его меньшего размера, шляпка без бугорка, колокольчатая, ножка гладкая, без хлопьев, с хорошо выраженным кольцом. У трех описанных наиболее опасных видов ядовитых грибов, вызывающих, по некоторым данным, до 90% всех смертельных случаев отравления грибами, имеется много съедобных двойников, что повышает вероятность их ошибочного сбора. Обычно наиболее похожими на эти виды считают шампиньоны лесной и полевой, однако при более внимательном взгляде их отличить довольно легко. Шампиньоны, правда, окраской шляпки и кольцом на ножке похожи на мухоморы вонючий и весенний и даже на более светлоокрашенные экземпляры бледной поганки, но отличаются отсутствием вольвы у основания ножки. Поэтому очень важно срывать шампиньон с ножкой, чтобы убедиться в отсутствии вольвы, а не срезать шляпки.
 Очень похожи съедобный мухомор серо-розовый и ядовитый мухомор пантерный
Очень похожи съедобный мухомор серо-розовый и ядовитый мухомор пантерный
 Очень похожи съедобный мухомор серо-розовый и ядовитый мухомор пантерный
Кроме того, у шампиньонов в отличие от мухоморов и бледной поганки пластинки имеют сначала грязно-розовую окраску, а при созревании спор темнеют до коричневых или черновато-бурых.
Очень опасно сходство бледной поганки с некоторыми сыроежками, имеющими окраску шляпки зеленых или даже оливковых тонов. Сходство здесь увеличивается еще и тем, что пластинки у сыроежек, как и у мухоморов, белые. Главный отличительный признак сыроежек зеленой, зеленоватой и некоторых других — отсутствие вольвы и кольца на ножке, поэтому при сборе грибов очень важно обращать внимание на детали строения ножки. Если у гриба с зеленой окраской шляпки и белыми пластинками есть кольцо на ножке и вздутие у основания ножки или хорошо заметная вольва — это ядовитый мухомор.
На бледную поганку и менее ядовитый мухомор поганковидный слегка похож и съедобный гриб зеленушка, однако у нее ножка и пластинки даже на ранних стадиях имеют зеленовато-желтую окраску, чем она легко отличается от мухоморов, а ножка ее лишена кольца и вольвы.
Наиболее опасно, пожалуй, сходство белого поплавка с мухомором вонючим. Эти грибы иногда трудно различить даже специалисту. У поплавков, в отличие от мухоморов, их близких родственников, есть вольва у основания ножки, но нет кольца. Однако ножка у них белая, чешуйчатая и очень похожа на ножку мухомора вонючего в тех случаях, когда у последнего бывает плохо выражено на ножке кольцо. Окраска шляпки и пластинок у обоих грибов белая и даже форма шляпки часто сходна, хотя у поплавка она обычно более правильной формы, конической или полукруглой, без резкого бугра. Единственный более или менее хорошо выраженный отличительный признак у этих видов — рубчатый или полосатый край шляпки у поплавка и гладкий у мухомора вонючего. Поплавки, в том числе и белый, — съедобные, поэтому при сборе особенно опасна возможность спутать их с мухомором вонючим.
Очень похожи съедобный мухомор серо-розовый и ядовитый мухомор пантерный
Кроме того, у шампиньонов в отличие от мухоморов и бледной поганки пластинки имеют сначала грязно-розовую окраску, а при созревании спор темнеют до коричневых или черновато-бурых.
Очень опасно сходство бледной поганки с некоторыми сыроежками, имеющими окраску шляпки зеленых или даже оливковых тонов. Сходство здесь увеличивается еще и тем, что пластинки у сыроежек, как и у мухоморов, белые. Главный отличительный признак сыроежек зеленой, зеленоватой и некоторых других — отсутствие вольвы и кольца на ножке, поэтому при сборе грибов очень важно обращать внимание на детали строения ножки. Если у гриба с зеленой окраской шляпки и белыми пластинками есть кольцо на ножке и вздутие у основания ножки или хорошо заметная вольва — это ядовитый мухомор.
На бледную поганку и менее ядовитый мухомор поганковидный слегка похож и съедобный гриб зеленушка, однако у нее ножка и пластинки даже на ранних стадиях имеют зеленовато-желтую окраску, чем она легко отличается от мухоморов, а ножка ее лишена кольца и вольвы.
Наиболее опасно, пожалуй, сходство белого поплавка с мухомором вонючим. Эти грибы иногда трудно различить даже специалисту. У поплавков, в отличие от мухоморов, их близких родственников, есть вольва у основания ножки, но нет кольца. Однако ножка у них белая, чешуйчатая и очень похожа на ножку мухомора вонючего в тех случаях, когда у последнего бывает плохо выражено на ножке кольцо. Окраска шляпки и пластинок у обоих грибов белая и даже форма шляпки часто сходна, хотя у поплавка она обычно более правильной формы, конической или полукруглой, без резкого бугра. Единственный более или менее хорошо выраженный отличительный признак у этих видов — рубчатый или полосатый край шляпки у поплавка и гладкий у мухомора вонючего. Поплавки, в том числе и белый, — съедобные, поэтому при сборе особенно опасна возможность спутать их с мухомором вонючим.
 Грибы-двойники: 1 — бледная поганка; 2 — зеленушка; 3 — сыроежка зеленая; 4 — мухомор вонючий; 5 — поплавок белый; 6 — мухомор серо-розовый; 7 — мухомор пантерный; 8 — шампиньон полевой; 9 — шампиньон обыкновенный
Другая группа грибов-двойников ядовитые мухоморы красный и пантерный и съедобные мухоморы серо-розовый и толстый. Всем хорошо известен красный мухомор — один из красивейших наших грибов: ярко-красная нарядная шляпка с белыми пятнышками остатков общего покрывала. На первый взгляд, его нельзя спутать с остальными грибами. Но это не так. С возрастом шляпка красного мухомора выцветает и желтеет, кроме того, иногда встречаются его более светлоокрашенные варианты и по окраске их можно спутать с мухомором серо-розовым, бледно-красноватая или серо-розоватая шляпка которого с возрастом, наоборот, становится более темной, красно-бурой . Сходны оба вида и по характеру вольвы у основания утолщенной ножки, имеющей вид белых хлопьев. Эти виды хорошо различаются лишь по окраске мякоти, особенно в ножке: у мухомора красного она белая и не изменяет окраски на разломе, а у мухомора серо-розового всегда имеет розоватый оттенок и на разломе розовеет, розоватый или красноватый оттенок имеют и пластинки зрелого плодового тела.
Еще легче спутать серо-розовый мухомор с пантерным, иногда очень похожим на него окраской шляпки — оранжево-бурой или серовато-бурой. От своего двойника пантерный мухомор отличается чисто белой мякотью, не изменяющей окраски на разломе.
Грибы-двойники: 1 — бледная поганка; 2 — зеленушка; 3 — сыроежка зеленая; 4 — мухомор вонючий; 5 — поплавок белый; 6 — мухомор серо-розовый; 7 — мухомор пантерный; 8 — шампиньон полевой; 9 — шампиньон обыкновенный
Другая группа грибов-двойников ядовитые мухоморы красный и пантерный и съедобные мухоморы серо-розовый и толстый. Всем хорошо известен красный мухомор — один из красивейших наших грибов: ярко-красная нарядная шляпка с белыми пятнышками остатков общего покрывала. На первый взгляд, его нельзя спутать с остальными грибами. Но это не так. С возрастом шляпка красного мухомора выцветает и желтеет, кроме того, иногда встречаются его более светлоокрашенные варианты и по окраске их можно спутать с мухомором серо-розовым, бледно-красноватая или серо-розоватая шляпка которого с возрастом, наоборот, становится более темной, красно-бурой . Сходны оба вида и по характеру вольвы у основания утолщенной ножки, имеющей вид белых хлопьев. Эти виды хорошо различаются лишь по окраске мякоти, особенно в ножке: у мухомора красного она белая и не изменяет окраски на разломе, а у мухомора серо-розового всегда имеет розоватый оттенок и на разломе розовеет, розоватый или красноватый оттенок имеют и пластинки зрелого плодового тела.
Еще легче спутать серо-розовый мухомор с пантерным, иногда очень похожим на него окраской шляпки — оранжево-бурой или серовато-бурой. От своего двойника пантерный мухомор отличается чисто белой мякотью, не изменяющей окраски на разломе.
 Грибы-двойники: 1 — поплавок серый; 2 — шампиньон лесной; 3 — мухомор порфировый; 4 — рядовка белая; 5 — говорушка восковатая; 6 — говорушка беловатая; 7 — ивишень
У ядовитых мухоморов есть еще один похожий на них двойник — мухомор толстый с буровато-серой, иногда желтовато-серой или даже зеленоватой шляпкой с беловатыми или сероватыми хлопьями от общего покрывала. Растет он в смешанных лесах с широколиственными породами и реже в хвойных в августе — сентябре. Опасность спутать этот гриб с мухоморами пантерным или с поганковидным очень велика, поэтому его часто не собирают и даже в руководствах по сбору грибов часто указывают, что он несъедобен.
Нередко красные мухоморы собирают вместо сыроежек с красной окраской шляпки. Действительно, если с возрастом мухомор утратил хлопья от покрывала на шляпке, а сборы были проведены небрежно и грибы в корзине или даже в полиэтиленовом пакете, или сумке слежались и поломались при транспортировке, при разборе таких грибов дома, особенно если они были взяты без ножек, весьма трудно отличить красный мухомор от крупных красных сыроежек — болотной и др. Во избежание опасности отравления такие грибы лучше выбросить, тем более, что даже сыроежки в таком состоянии могут быть его причиной.
Грибы-двойники: 1 — поплавок серый; 2 — шампиньон лесной; 3 — мухомор порфировый; 4 — рядовка белая; 5 — говорушка восковатая; 6 — говорушка беловатая; 7 — ивишень
У ядовитых мухоморов есть еще один похожий на них двойник — мухомор толстый с буровато-серой, иногда желтовато-серой или даже зеленоватой шляпкой с беловатыми или сероватыми хлопьями от общего покрывала. Растет он в смешанных лесах с широколиственными породами и реже в хвойных в августе — сентябре. Опасность спутать этот гриб с мухоморами пантерным или с поганковидным очень велика, поэтому его часто не собирают и даже в руководствах по сбору грибов часто указывают, что он несъедобен.
Нередко красные мухоморы собирают вместо сыроежек с красной окраской шляпки. Действительно, если с возрастом мухомор утратил хлопья от покрывала на шляпке, а сборы были проведены небрежно и грибы в корзине или даже в полиэтиленовом пакете, или сумке слежались и поломались при транспортировке, при разборе таких грибов дома, особенно если они были взяты без ножек, весьма трудно отличить красный мухомор от крупных красных сыроежек — болотной и др. Во избежание опасности отравления такие грибы лучше выбросить, тем более, что даже сыроежки в таком состоянии могут быть его причиной.
 Ядовитые волоконницы внешне малопримечательны
Ядовитые волоконницы — земляная, изорванная и др. обычно имеют мелкие, мало привлекательные плодовые тела, и сбор их маловероятен. Опасность представляет только смертельно ядовитая волоконница Патуйяра со шляпкой до 3-8 см в диаметре, имеющей обычно в молодом возрасте беловатую окраску, а в зрелом красноватую или желтовато-красноватую. Встречается этот гриб в лиственных и хвойных лесах с августа по сентябрь, а в некоторых странах Западной и Центральной Европы даже раньше, начиная с июня. В наших лесах нет съедобных грибов, похожих на волоконницу Патуйяра, однако неопытный грибник может иногда принять ее молодые плодовые тела за шампиньоны, тем более, что пластинки у них вначале розовые, а затем довольно темные, коричневые с красноватыми пятнами. В этих случаях нужно обращать внимание на ножку гриба и окраску спорового порошка. У волоконниц кольцо на ножке отсутствует и споровый порошок желто-бурый, а у шампиньона есть кольцо на ножке и споровый порошок темно-коричнево-фиолетовый.
Ядовитые волоконницы внешне малопримечательны
Ядовитые волоконницы — земляная, изорванная и др. обычно имеют мелкие, мало привлекательные плодовые тела, и сбор их маловероятен. Опасность представляет только смертельно ядовитая волоконница Патуйяра со шляпкой до 3-8 см в диаметре, имеющей обычно в молодом возрасте беловатую окраску, а в зрелом красноватую или желтовато-красноватую. Встречается этот гриб в лиственных и хвойных лесах с августа по сентябрь, а в некоторых странах Западной и Центральной Европы даже раньше, начиная с июня. В наших лесах нет съедобных грибов, похожих на волоконницу Патуйяра, однако неопытный грибник может иногда принять ее молодые плодовые тела за шампиньоны, тем более, что пластинки у них вначале розовые, а затем довольно темные, коричневые с красноватыми пятнами. В этих случаях нужно обращать внимание на ножку гриба и окраску спорового порошка. У волоконниц кольцо на ножке отсутствует и споровый порошок желто-бурый, а у шампиньона есть кольцо на ножке и споровый порошок темно-коричнево-фиолетовый.
 Смертельно ядовитый гриб — паутинник оранжево-красный
Наиболее опасные из ядовитых говорушек — беловатая, восковатая и др. — обычно имеют плодовые тела средних и мелких размеров, со шляпкой от 2 до 7 см диаметром, с частыми узкими пластинками, более или менее сильно низбегающими по ножке. Их окраска обычно беловатая или грязно-беловатая, иногда с сероватым оттенком. И по размерам плодовых тел, и по их окраске эти виды не похожи на съедобные, иногда собираемые грибниками говорушки — ворончатую, серую или булавоногую, поэтому опасности смешения их с этими видами нет. Однако ядовитые говорушки похожи на съедобный малоизвестный гриб из этого же семейства — подвишень, или ивишень, который встречается с июля по сентябрь в широколиственных, реже березовых и хвойных с примесью березы лесах, а также на лугах и в садах, т. е. в тех же местообитаниях и в те же сроки что и ядовитые говорушки. Основное отличие подвишеня от ядовитых говорушек — розоватые пластинки и розовый споровый порошок; у говорушек и пластинки и споровый порошок белые.
Еще один смертельно ядовитый гриб, токсичность которого была установлена относительно недавно, в 50-е годы, — паутинник оранжево-красный. Это малоизвестный у нас ядовитый гриб, и хотя он и не имеет съедобных двойников его отличительные признаки следует знать. Шляпка у этого гриба диаметром до 8 см, апельсиново-оранжевая, иногда красноватая со слегка войлочной поверхностью, иногда с тонкими темными волокнами; пластинки оранжево-охряные или оранжево-ржавые с характерным апельсиново-красным оттенком; ножка сужена к основанию, желтоватая, с возрастом сереющая; мякоть плодового тела желтоватая, со слабым запахом редьки. У молодых плодовых тел имеется (как и у всех паутинников) кортина — паутинистое частное покрывало. Споровый порошок коричневый. Из этого описания видно, что паутинник оранжево-красный сходен лишь с некоторыми другими паутинниками, но поскольку съедобные паутинники не пользуются у нас популярностью, опасность сбора оранжево-красного вместо какого-либо из них невелика.
Смертельно ядовитый гриб — паутинник оранжево-красный
Наиболее опасные из ядовитых говорушек — беловатая, восковатая и др. — обычно имеют плодовые тела средних и мелких размеров, со шляпкой от 2 до 7 см диаметром, с частыми узкими пластинками, более или менее сильно низбегающими по ножке. Их окраска обычно беловатая или грязно-беловатая, иногда с сероватым оттенком. И по размерам плодовых тел, и по их окраске эти виды не похожи на съедобные, иногда собираемые грибниками говорушки — ворончатую, серую или булавоногую, поэтому опасности смешения их с этими видами нет. Однако ядовитые говорушки похожи на съедобный малоизвестный гриб из этого же семейства — подвишень, или ивишень, который встречается с июля по сентябрь в широколиственных, реже березовых и хвойных с примесью березы лесах, а также на лугах и в садах, т. е. в тех же местообитаниях и в те же сроки что и ядовитые говорушки. Основное отличие подвишеня от ядовитых говорушек — розоватые пластинки и розовый споровый порошок; у говорушек и пластинки и споровый порошок белые.
Еще один смертельно ядовитый гриб, токсичность которого была установлена относительно недавно, в 50-е годы, — паутинник оранжево-красный. Это малоизвестный у нас ядовитый гриб, и хотя он и не имеет съедобных двойников его отличительные признаки следует знать. Шляпка у этого гриба диаметром до 8 см, апельсиново-оранжевая, иногда красноватая со слегка войлочной поверхностью, иногда с тонкими темными волокнами; пластинки оранжево-охряные или оранжево-ржавые с характерным апельсиново-красным оттенком; ножка сужена к основанию, желтоватая, с возрастом сереющая; мякоть плодового тела желтоватая, со слабым запахом редьки. У молодых плодовых тел имеется (как и у всех паутинников) кортина — паутинистое частное покрывало. Споровый порошок коричневый. Из этого описания видно, что паутинник оранжево-красный сходен лишь с некоторыми другими паутинниками, но поскольку съедобные паутинники не пользуются у нас популярностью, опасность сбора оранжево-красного вместо какого-либо из них невелика.
 Грибы-двойники: 1 — ложноопенок китпично-красный; 2 — ложноопенок серно-желтый; 3 — опенок осенний; 4 — опенок летний; 5 — огневка ольховая; 6 — зимний гриб
Наиболее известные грибы-двойники — опенки: съедобные летние, осенние и зимние (зимний гриб) и ядовитые ложноопенки — серно-желтый и кирпично-красный. Ложноопенки большей частью не вызывают опасных для жизни отравлений, но поскольку их очень часто путают с настоящими опенками, необходимо знать основные отличительные признаки этих грибов. Оба вида ложноопенков отличаются от настоящих опенков прежде всего окраской пластинок: у серно-желтого они сначала серно-желтые, а у кирпично-красного — беловатые или грязно-желтые, но по мере образования спор очень быстро темнеют, приобретая черновато-оливковую или оливково-бурую окраску. У летнего опенка они вначале кремовые, позднее буреющие, а у осеннего опенка и зимнего гриба — белые или желтоватые и никогда не темнеют. Зеленовато-оливковый оттенок пластинок у грибов с темным споровым порошком, растущих большими группами на пнях, на почве около них или реже на живых стволах деревьев — признак ложноопенков, надежно отличающий их от настоящих опенков.
Грибы-двойники: 1 — ложноопенок китпично-красный; 2 — ложноопенок серно-желтый; 3 — опенок осенний; 4 — опенок летний; 5 — огневка ольховая; 6 — зимний гриб
Наиболее известные грибы-двойники — опенки: съедобные летние, осенние и зимние (зимний гриб) и ядовитые ложноопенки — серно-желтый и кирпично-красный. Ложноопенки большей частью не вызывают опасных для жизни отравлений, но поскольку их очень часто путают с настоящими опенками, необходимо знать основные отличительные признаки этих грибов. Оба вида ложноопенков отличаются от настоящих опенков прежде всего окраской пластинок: у серно-желтого они сначала серно-желтые, а у кирпично-красного — беловатые или грязно-желтые, но по мере образования спор очень быстро темнеют, приобретая черновато-оливковую или оливково-бурую окраску. У летнего опенка они вначале кремовые, позднее буреющие, а у осеннего опенка и зимнего гриба — белые или желтоватые и никогда не темнеют. Зеленовато-оливковый оттенок пластинок у грибов с темным споровым порошком, растущих большими группами на пнях, на почве около них или реже на живых стволах деревьев — признак ложноопенков, надежно отличающий их от настоящих опенков.
Токсины грибов
Ядовитые свойства грибов были известны людям уже в глубокой древности. Еще греческие и римские писатели сообщали о смертельных отравлениях грибами, а история донесла до наших дней имена многих известных личностей, ставших их жертвами. Среди них — римский император Клавдий, французский король Карл VI, папа римский Климент VII и др. Уже в древности ученые пытались объяснить природу ядовитого действия грибов. Греческий врач Диоскорид в середине I в. до нашей эры высказал предположение, что грибы получают свои ядовитые свойства из окружающей их среды, вырастая около ржавого железа, разлагающегося мусора, змеиных нор или даже растений с ядовитыми плодами. Эта гипотеза просуществовала много лет. Ее поддерживали Плиний и многие ученые и писатели средних веков — Альберт Великий, Джон Герард и др. И лишь высокий уровень развития химии в XX в. позволил получить в чистом виде содержащиеся в этих грибах ядовитые вещества, изучить их свойства и установить химическое строение. Ложнодождевик
Токсины ядовитых грибов по характеру вызываемых ими отравлений подразделяют на три основные группы. Первую из них составляют вещества с местным раздражающим действием, вызывающие обычно нарушение функций системы пищеварения. Их действие проявляется быстро, иногда уже через 15 мин, самое позднее через 30-60 мин. Многие грибы, образующие токсины этой группы (некоторые сыроежки и млечники с едким вкусом, недоваренные осенние опенки, сатанинский гриб, шампиньоны пестрый и желтокожий, ложные дождевики и др.), вызывают довольно легкие, не угрожающие жизни отравления, проходящие в течение 2- 4 дней. Однако среди этих грибов есть отдельные виды, могущие вызвать и опасные для жизни отравления, например рядовка тигровая. Известен случай, когда попавшая в грибное блюдо рядовка (единственный гриб) вызвала тяжелое отравление у 5 человек. Известны и случаи массового отравления этими грибами, проданными как шампиньоны.
Ложнодождевик
Токсины ядовитых грибов по характеру вызываемых ими отравлений подразделяют на три основные группы. Первую из них составляют вещества с местным раздражающим действием, вызывающие обычно нарушение функций системы пищеварения. Их действие проявляется быстро, иногда уже через 15 мин, самое позднее через 30-60 мин. Многие грибы, образующие токсины этой группы (некоторые сыроежки и млечники с едким вкусом, недоваренные осенние опенки, сатанинский гриб, шампиньоны пестрый и желтокожий, ложные дождевики и др.), вызывают довольно легкие, не угрожающие жизни отравления, проходящие в течение 2- 4 дней. Однако среди этих грибов есть отдельные виды, могущие вызвать и опасные для жизни отравления, например рядовка тигровая. Известен случай, когда попавшая в грибное блюдо рядовка (единственный гриб) вызвала тяжелое отравление у 5 человек. Известны и случаи массового отравления этими грибами, проданными как шампиньоны.
 Рядовка тигровая
Очень токсичны грибы — энтолома выемчатая и некоторые другие виды энтолом. Симптомы отравления рядовкой тигровой и ядовитыми энтоломами сходны и напоминают симптомы холеры: тошнота, рвота, сильная потеря организмом воды в результате стойкого поноса и, как результат этого, сильная жажда, резкие боли в животе, слабость и часто потеря сознания. Симптомы появляются очень быстро, через 30 мин и не позднее 1-2 ч после употребления грибов в пищу. Заболевание продолжается от 2 дней до недели и у взрослых здоровых людей заканчивается обычно полным выздоровлением. Однако у детей и лиц, ослабленных перенесенными болезнями, токсины этих грибов могут вызвать смертельный исход. Структура токсинов этой группы пока не установлена. Ко второй группе относятся токсины с нейротропным действием, т. е. вызывающие в первую очередь нарушения деятельности центральной нервной системы. Симптомы отравления проявляются тоже через 30 мин — 1-2 ч: приступы смеха или плача, галлюцинации, потеря сознания, расстройство пищеварения. В отличие от токсинов первой группы токсины нейротропного действия достаточно хорошо исследованы. Они обнаружены преимущественно у мухоморов — красного, пантерного, шишковидного, поганковидного, а также у некоторых волоконниц, говорушек, рядовок, в очень небольшом количестве у синяка, сыроежки рвотной, некоторых гебелом и энтолом.
Исследования токсинов красного мухомора были начаты еще в середине прошлого века, и в 1869 г. немецкие исследователи Шмидеберг и Коппе выделили из него алкалоид, по своему действию близкий к ацетилхолину и названный мускарином. Исследователи предполагали, что ими открыт основной токсин красного мухомора, однако оказалось, что он содержится в этом грибе в очень малых количествах — всего около 0,0002% массы свежих грибов. Позднее значительно большее содержание этого вещества было найдено в других грибах (в волоконнице Патуйяра — до 0,037%).
При действии мускарина наблюдается сильное сужение зрачков, замедляются пульс и дыхание, снижается кровяное давление, а также повышается секреторная деятельность потовых желез и слизистых оболочек носа и ротовой полости. Смертельная доза этого токсина для человека, 300-500 мг, содержится в 40-80 г волоконницы Патуйяра и в 3-4 кг красного мухомора. При отравлении мускарином очень эффективен атропин, быстро восстанавливающий нормальную работу сердца; при своевременном применении этого препарата выздоровление наступает через 1-2 дня.
Действие чистого мускарина воспроизводит только симптомы периферических явлений, наблюдающихся при отравлении красным мухомором, но не его психотропное действие. Поэтому поиски токсина этого гриба продолжались и привели к открытию у него трех активных веществ с психотропным действием — иботеновой кислоты, мусцимола и мусказона. Эти соединения близки между собой: мусцимол, основной токсин красного мухомора, содержащийся в нем в количестве 0,03- 0,1% массы свежих грибов, представляет собой производное иботеновой кислоты. В дальнейшем эти токсины были обнаружены и у других ядовитых грибов — у мухоморов шишковидного и пантерного (иботеновая кислота) и у одной из рядовок (трихоломовая кислота — производное иботеновой кислоты). Оказалось, что именно эта группа токсинов вызывает характерные симптомы отравления красным мухомором — возбуждение, сопровождающееся галлюцинациями и сменяющееся через некоторое время наркозоподобной паралитической стадией с продолжительным глубоким сном, сильной усталостью и потерей сознания. Иботеновая кислота и ее производные по своему действию на организм сходны с атропином, поэтому это средство, используемое при отравлении мускарином, нельзя применять при отравлении красным или пантерным мухоморам. При таком отравлении очищают желудок и кишечник и дают лекарственные средства для снятия возбуждения и нормализации сердечной деятельности и дыхания. Как и при отравлении мускарином, больного необходимо уложить в постель и срочно вызвать врача. При отсутствии квалифицированной медицинской помощи эти токсины могут вызвать смерть больного.
Действие этих токсинов в известной мере напоминает опьянение под действием алкогольных напитков. Американские исследователи Р. Дж. и В. П. Уоссоны в книге "Грибы, Россия и история", опубликованной в 1957 г., приводят сведения об использовании народами Сибири этого гриба в качестве ритуального средства еще в глубокой древности: под его действием человек приходил в состояние экстаза и галлюцинаций. Сохранились сообщения о том, что в древней Скандинавии существовали специальные отряды воинов-берсеркеров, которые перед боем съедали кусочки мухомора или выпивали напиток из него и впадали под действием содержащихся в нем токсинов в состояние бешеной ярости. Они не чувствовали ран и ударов оружия и шли, сметая все на своем пути.
С образованием иботеновой кислоты и мусцимола связано и токсическое действие мухоморов на насекомых, в частности на мух, откуда, вероятно, и происходит название этих грибов.
У некоторых мухоморов, например поганковидного и порфирного, обнаружена довольно высокая концентрация токсинов иного химического строения, обладающих сильно выраженным психотропным действием.
Грибы другой группы — виды псилоцибе и другие представители строфариевых — также обладают очень сильным галлюциногенным действием. Сведения об использовании галлюциногенных грибов в ритуальных обрядах индейцев Центральной и Южной Америки можно встретить в рукописях XVI-XVII вв., где есть упоминания о божественном грибе "теонанакатл". Во время раскопок в Гватемале были обнаружены каменные скульптуры, изображающие мифические существа с поднимающимися над ними грибами. Р. Дж. и В. П. Уоссонам удалось в горном районе Мексики присутствовать при сохранившемся здесь древнем языческом ритуале, связанном с грибами, обладающими якобы магическим действием. Съев эти грибы, люди впадали в состояние транса и галлюцинаций. Позднее, при участии французского миколога Р. Эйма удалось выяснить, что представляют собой ритуальные грибы древних индейских племен. Это был новый вид из рода псилоцибе. В дальнейшем из этих грибов были выделены психотропные вещества, исследованы их структура и свойства. Оказалось, что грибы содержат два близких соединения — псилоцибин и псилоцин; сейчас известно их строение, и эти вещества получены путем химического синтеза.
Фармакологические исследования показали, что псилоцибин не ядовит, т. е. не является токсином в строгом смысле. Характер его действия зависит от дозы: уже 1 мг этого вещества вызывает через полчаса состояние легкого опьянения, при увеличении дозы до 2-3 мг наступает состояние нервного расслабления и отрешения от действительности, а при дозе до 60 мг и выше появляются галлюцинации и состояние наркотического полусна. Псилоцибин используется в медицинской практике для лечения некоторых психических заболеваний. Он обнаружен у большого числа грибов из семейства строфариевых — разных видов псилоцибе, некоторых строфарий и др. Кроме галлюциногенов, у видов псилоцибе обнаружены и два алкалоида, нарушающие деятельность коры головного мозга.
Третья группа токсинов шляпочных грибов, самая большая и важная, — это смертельно ядовитые токсины бледной поганки, мухоморов вонючего и весеннего и близкие к ним по некоторым особенностям действия на организм токсины строчков и многих лопастников, а также паутинника оранжево-красного. Особая опасность этих токсинов в том, что, попав в организм, они в течение длительного времени, до 24-48 ч, не вызывают никаких заметных симптомов. Только после латентного (скрытого) периода, в течение которого токсины уже вызывают часто необратимые изменения в некоторых внутренних органах, например печени или почках, появляются первые признаки отравления — усиление деятельности мускулатуры кишечника и как результат этого, сильная рвота и понос. Эти явления приводят к сильному обезвоживания организма, что сопровождается сгущением крови и жаждой. Затем наступает падение кровяного давления, и на этой стадии нередко наступает временное улучшение, но к этому времени в организме уже произошло необратимое повреждение печени, сердца и почек, поэтому состояние больного снова ухудшается и, если своевременно, еще до развития симптомов отравления или в самом его начале, больному не была оказана срочная медицинская помощь, наступает смерть.
Первые работы по токсинам бледной поганки, вызывающей, по данным медицинской статистики, до 90-95% всех смертельных случаев отравления грибами, появились еще в начале нашего века. В 1937 г. исследователям Ф. Линену и У. Виланду в Мюнхенской химической лаборатории удалось получить в кристаллическом виде первый токсин, названный ими фаллоидином, а 4 года спустя в той же лаборатории был выделен второй токсин — аманитин. Современный период исследования этих токсинов связан с именем немецкого ученого Т. Виланда, работающего в отделе химии института Макса Планка в Гейдельберге. Ему и его сотрудникам удалось показать, что аманитин и фаллоидин — это комплексы, состоящие каждый из нескольких компонентов, и получившие название соответственно аматоксины и фаллотоксины.
Отравление токсинами бледной поганки вызывает некроз клеток печени, а в более тяжелых случаях — и почек. Действие их начинается уже через 30 мин, не проявляясь, как уже отмечалось, никакими внешними симптомами. Максимальные повреждения организма происходят через 2-3 дня. Прогноз исхода заболевания определяется тем, насколько тяжело поражена печень. Даже при своевременно начатом лечении смертельный исход наблюдается в 8-30% случаев. Сейчас разработаны методы лечения отравлений бледной поганкой, направленные в первую очередь на нормализацию функций печени. Ведутся интенсивные поиски новых лечебных средств. В опытах на животных удалось снизить летальность отравлений с 58 до 20%. Из бледной поганки и мухомора вонючего было получено вещество белковой природы, нейтрализующее действие токсинов этих грибов. Во Франции ученые работают над сыворотками, защищающими организм от отравления токсинами бледной поганки. Эти сыворотки уже испытываются в клинических условиях.
По данным, полученным Т. Виландом с сотрудниками в 1980 г., мухомор вонючий содержит еще один токсин, отсутствующий у бледной поганки, в количестве 0,5- 0,9 мг на 1 г массы грибов.
У перечисленных видов мухоморовых встречается также белковый токсин, вызывающий гемолиз (растворение эритроцитов крови). Подобные гемолитические белки найдены в последнее время и у некоторых съедобных грибов — вешенки, вольвариеллы, зимнего гриба и мухомора серо-розового. Однако эти токсины при температуре 70oС разрушаются и, следовательно, полностью обезвреживаются при отваривании и жарении грибов.
Рядовка тигровая
Очень токсичны грибы — энтолома выемчатая и некоторые другие виды энтолом. Симптомы отравления рядовкой тигровой и ядовитыми энтоломами сходны и напоминают симптомы холеры: тошнота, рвота, сильная потеря организмом воды в результате стойкого поноса и, как результат этого, сильная жажда, резкие боли в животе, слабость и часто потеря сознания. Симптомы появляются очень быстро, через 30 мин и не позднее 1-2 ч после употребления грибов в пищу. Заболевание продолжается от 2 дней до недели и у взрослых здоровых людей заканчивается обычно полным выздоровлением. Однако у детей и лиц, ослабленных перенесенными болезнями, токсины этих грибов могут вызвать смертельный исход. Структура токсинов этой группы пока не установлена. Ко второй группе относятся токсины с нейротропным действием, т. е. вызывающие в первую очередь нарушения деятельности центральной нервной системы. Симптомы отравления проявляются тоже через 30 мин — 1-2 ч: приступы смеха или плача, галлюцинации, потеря сознания, расстройство пищеварения. В отличие от токсинов первой группы токсины нейротропного действия достаточно хорошо исследованы. Они обнаружены преимущественно у мухоморов — красного, пантерного, шишковидного, поганковидного, а также у некоторых волоконниц, говорушек, рядовок, в очень небольшом количестве у синяка, сыроежки рвотной, некоторых гебелом и энтолом.
Исследования токсинов красного мухомора были начаты еще в середине прошлого века, и в 1869 г. немецкие исследователи Шмидеберг и Коппе выделили из него алкалоид, по своему действию близкий к ацетилхолину и названный мускарином. Исследователи предполагали, что ими открыт основной токсин красного мухомора, однако оказалось, что он содержится в этом грибе в очень малых количествах — всего около 0,0002% массы свежих грибов. Позднее значительно большее содержание этого вещества было найдено в других грибах (в волоконнице Патуйяра — до 0,037%).
При действии мускарина наблюдается сильное сужение зрачков, замедляются пульс и дыхание, снижается кровяное давление, а также повышается секреторная деятельность потовых желез и слизистых оболочек носа и ротовой полости. Смертельная доза этого токсина для человека, 300-500 мг, содержится в 40-80 г волоконницы Патуйяра и в 3-4 кг красного мухомора. При отравлении мускарином очень эффективен атропин, быстро восстанавливающий нормальную работу сердца; при своевременном применении этого препарата выздоровление наступает через 1-2 дня.
Действие чистого мускарина воспроизводит только симптомы периферических явлений, наблюдающихся при отравлении красным мухомором, но не его психотропное действие. Поэтому поиски токсина этого гриба продолжались и привели к открытию у него трех активных веществ с психотропным действием — иботеновой кислоты, мусцимола и мусказона. Эти соединения близки между собой: мусцимол, основной токсин красного мухомора, содержащийся в нем в количестве 0,03- 0,1% массы свежих грибов, представляет собой производное иботеновой кислоты. В дальнейшем эти токсины были обнаружены и у других ядовитых грибов — у мухоморов шишковидного и пантерного (иботеновая кислота) и у одной из рядовок (трихоломовая кислота — производное иботеновой кислоты). Оказалось, что именно эта группа токсинов вызывает характерные симптомы отравления красным мухомором — возбуждение, сопровождающееся галлюцинациями и сменяющееся через некоторое время наркозоподобной паралитической стадией с продолжительным глубоким сном, сильной усталостью и потерей сознания. Иботеновая кислота и ее производные по своему действию на организм сходны с атропином, поэтому это средство, используемое при отравлении мускарином, нельзя применять при отравлении красным или пантерным мухоморам. При таком отравлении очищают желудок и кишечник и дают лекарственные средства для снятия возбуждения и нормализации сердечной деятельности и дыхания. Как и при отравлении мускарином, больного необходимо уложить в постель и срочно вызвать врача. При отсутствии квалифицированной медицинской помощи эти токсины могут вызвать смерть больного.
Действие этих токсинов в известной мере напоминает опьянение под действием алкогольных напитков. Американские исследователи Р. Дж. и В. П. Уоссоны в книге "Грибы, Россия и история", опубликованной в 1957 г., приводят сведения об использовании народами Сибири этого гриба в качестве ритуального средства еще в глубокой древности: под его действием человек приходил в состояние экстаза и галлюцинаций. Сохранились сообщения о том, что в древней Скандинавии существовали специальные отряды воинов-берсеркеров, которые перед боем съедали кусочки мухомора или выпивали напиток из него и впадали под действием содержащихся в нем токсинов в состояние бешеной ярости. Они не чувствовали ран и ударов оружия и шли, сметая все на своем пути.
С образованием иботеновой кислоты и мусцимола связано и токсическое действие мухоморов на насекомых, в частности на мух, откуда, вероятно, и происходит название этих грибов.
У некоторых мухоморов, например поганковидного и порфирного, обнаружена довольно высокая концентрация токсинов иного химического строения, обладающих сильно выраженным психотропным действием.
Грибы другой группы — виды псилоцибе и другие представители строфариевых — также обладают очень сильным галлюциногенным действием. Сведения об использовании галлюциногенных грибов в ритуальных обрядах индейцев Центральной и Южной Америки можно встретить в рукописях XVI-XVII вв., где есть упоминания о божественном грибе "теонанакатл". Во время раскопок в Гватемале были обнаружены каменные скульптуры, изображающие мифические существа с поднимающимися над ними грибами. Р. Дж. и В. П. Уоссонам удалось в горном районе Мексики присутствовать при сохранившемся здесь древнем языческом ритуале, связанном с грибами, обладающими якобы магическим действием. Съев эти грибы, люди впадали в состояние транса и галлюцинаций. Позднее, при участии французского миколога Р. Эйма удалось выяснить, что представляют собой ритуальные грибы древних индейских племен. Это был новый вид из рода псилоцибе. В дальнейшем из этих грибов были выделены психотропные вещества, исследованы их структура и свойства. Оказалось, что грибы содержат два близких соединения — псилоцибин и псилоцин; сейчас известно их строение, и эти вещества получены путем химического синтеза.
Фармакологические исследования показали, что псилоцибин не ядовит, т. е. не является токсином в строгом смысле. Характер его действия зависит от дозы: уже 1 мг этого вещества вызывает через полчаса состояние легкого опьянения, при увеличении дозы до 2-3 мг наступает состояние нервного расслабления и отрешения от действительности, а при дозе до 60 мг и выше появляются галлюцинации и состояние наркотического полусна. Псилоцибин используется в медицинской практике для лечения некоторых психических заболеваний. Он обнаружен у большого числа грибов из семейства строфариевых — разных видов псилоцибе, некоторых строфарий и др. Кроме галлюциногенов, у видов псилоцибе обнаружены и два алкалоида, нарушающие деятельность коры головного мозга.
Третья группа токсинов шляпочных грибов, самая большая и важная, — это смертельно ядовитые токсины бледной поганки, мухоморов вонючего и весеннего и близкие к ним по некоторым особенностям действия на организм токсины строчков и многих лопастников, а также паутинника оранжево-красного. Особая опасность этих токсинов в том, что, попав в организм, они в течение длительного времени, до 24-48 ч, не вызывают никаких заметных симптомов. Только после латентного (скрытого) периода, в течение которого токсины уже вызывают часто необратимые изменения в некоторых внутренних органах, например печени или почках, появляются первые признаки отравления — усиление деятельности мускулатуры кишечника и как результат этого, сильная рвота и понос. Эти явления приводят к сильному обезвоживания организма, что сопровождается сгущением крови и жаждой. Затем наступает падение кровяного давления, и на этой стадии нередко наступает временное улучшение, но к этому времени в организме уже произошло необратимое повреждение печени, сердца и почек, поэтому состояние больного снова ухудшается и, если своевременно, еще до развития симптомов отравления или в самом его начале, больному не была оказана срочная медицинская помощь, наступает смерть.
Первые работы по токсинам бледной поганки, вызывающей, по данным медицинской статистики, до 90-95% всех смертельных случаев отравления грибами, появились еще в начале нашего века. В 1937 г. исследователям Ф. Линену и У. Виланду в Мюнхенской химической лаборатории удалось получить в кристаллическом виде первый токсин, названный ими фаллоидином, а 4 года спустя в той же лаборатории был выделен второй токсин — аманитин. Современный период исследования этих токсинов связан с именем немецкого ученого Т. Виланда, работающего в отделе химии института Макса Планка в Гейдельберге. Ему и его сотрудникам удалось показать, что аманитин и фаллоидин — это комплексы, состоящие каждый из нескольких компонентов, и получившие название соответственно аматоксины и фаллотоксины.
Отравление токсинами бледной поганки вызывает некроз клеток печени, а в более тяжелых случаях — и почек. Действие их начинается уже через 30 мин, не проявляясь, как уже отмечалось, никакими внешними симптомами. Максимальные повреждения организма происходят через 2-3 дня. Прогноз исхода заболевания определяется тем, насколько тяжело поражена печень. Даже при своевременно начатом лечении смертельный исход наблюдается в 8-30% случаев. Сейчас разработаны методы лечения отравлений бледной поганкой, направленные в первую очередь на нормализацию функций печени. Ведутся интенсивные поиски новых лечебных средств. В опытах на животных удалось снизить летальность отравлений с 58 до 20%. Из бледной поганки и мухомора вонючего было получено вещество белковой природы, нейтрализующее действие токсинов этих грибов. Во Франции ученые работают над сыворотками, защищающими организм от отравления токсинами бледной поганки. Эти сыворотки уже испытываются в клинических условиях.
По данным, полученным Т. Виландом с сотрудниками в 1980 г., мухомор вонючий содержит еще один токсин, отсутствующий у бледной поганки, в количестве 0,5- 0,9 мг на 1 г массы грибов.
У перечисленных видов мухоморовых встречается также белковый токсин, вызывающий гемолиз (растворение эритроцитов крови). Подобные гемолитические белки найдены в последнее время и у некоторых съедобных грибов — вешенки, вольвариеллы, зимнего гриба и мухомора серо-розового. Однако эти токсины при температуре 70oС разрушаются и, следовательно, полностью обезвреживаются при отваривании и жарении грибов.
 Опасный токсин (гиромитрин) обнаружен у лопастников — грибов, близких к сморчкам и строчкам
Опасный токсин содержат строчки обыкновенный и гигантский, а также виды из рода гельвелла — лопастник. Он отличается от токсинов бледной поганки и других-грибов по строению, но сходен с ними по некоторым особенностям действия на организм. В строчках его может быть до 0,5% массы сухих грибов. Происхождение этого токсина до сих пор неизвестно, некоторые ученые предполагают, что он образуется в результате разложения белков в перезрелых плодовых телах грибов. Токсин растворим в горячей воде и может быть удален из грибов при кипячении и последующей промывке. Однако известный миколог Р. Г. Бенедикт считает, что лучший способ предохранить себя от отравлений этим токсином — не есть вообще строчки.
Интересно отметить, что отравления строчками отмечены не во всех странах, где их употребляют в пищу. Так, в ФРГ случаи отравления очень часты и продажа этих грибов на рынках была запрещена еще в прошлом веке. Во многих районах нашей страны строчки употребляются в пищу без особых последствий и допущены к заготовке и продаже как условно съедобные грибы согласно "Санитарным правилам по заготовке, переработке и продаже грибов", изданным Министерством здравоохранения СССР в 1981 г. Причины различной токсичности строчков в разных районах земного шара неизвестны. Предполагают, что биосинтез зависит от условий произрастания грибов или распространения в разных местностях вариантов гриба с разной способностью к синтезу токсина.
Симптомы отравления токсином, содержащимся в строчках, проявляются через 6-10 ч и могут продолжаться 1-2 дня. Это чувство полноты в желудке, сильная рвота и водяной понос, а также головная боль, усталость, сильные боли в области печени и желудка, судороги и желтуха. В наиболее острых случаях наблюдается нарушение пульса, одышка, конвульсии и бред. Нарушение функции легких и сердечная недостаточность в течение 5-10 дней могут вызвать смерть. Отравление строчками представляет опасность и по другой причине. Токсины, содержащиеся в этих грибах, и продукты их превращения обладают канцерогенными свойствами, под их действием возможно образование злокачественных опухолей (показано опытами на животных).
Опасный токсин (гиромитрин) обнаружен у лопастников — грибов, близких к сморчкам и строчкам
Опасный токсин содержат строчки обыкновенный и гигантский, а также виды из рода гельвелла — лопастник. Он отличается от токсинов бледной поганки и других-грибов по строению, но сходен с ними по некоторым особенностям действия на организм. В строчках его может быть до 0,5% массы сухих грибов. Происхождение этого токсина до сих пор неизвестно, некоторые ученые предполагают, что он образуется в результате разложения белков в перезрелых плодовых телах грибов. Токсин растворим в горячей воде и может быть удален из грибов при кипячении и последующей промывке. Однако известный миколог Р. Г. Бенедикт считает, что лучший способ предохранить себя от отравлений этим токсином — не есть вообще строчки.
Интересно отметить, что отравления строчками отмечены не во всех странах, где их употребляют в пищу. Так, в ФРГ случаи отравления очень часты и продажа этих грибов на рынках была запрещена еще в прошлом веке. Во многих районах нашей страны строчки употребляются в пищу без особых последствий и допущены к заготовке и продаже как условно съедобные грибы согласно "Санитарным правилам по заготовке, переработке и продаже грибов", изданным Министерством здравоохранения СССР в 1981 г. Причины различной токсичности строчков в разных районах земного шара неизвестны. Предполагают, что биосинтез зависит от условий произрастания грибов или распространения в разных местностях вариантов гриба с разной способностью к синтезу токсина.
Симптомы отравления токсином, содержащимся в строчках, проявляются через 6-10 ч и могут продолжаться 1-2 дня. Это чувство полноты в желудке, сильная рвота и водяной понос, а также головная боль, усталость, сильные боли в области печени и желудка, судороги и желтуха. В наиболее острых случаях наблюдается нарушение пульса, одышка, конвульсии и бред. Нарушение функции легких и сердечная недостаточность в течение 5-10 дней могут вызвать смерть. Отравление строчками представляет опасность и по другой причине. Токсины, содержащиеся в этих грибах, и продукты их превращения обладают канцерогенными свойствами, под их действием возможно образование злокачественных опухолей (показано опытами на животных).
 Розовопластинник весенний — один из самых ранних ядовитых грибов, появляется он в апреле на опушках леса, в садах и скверах
Есть еще один токсин, по продолжительности латентного периода даже превосходящий токсины бледной поганки. Его содержит паутинник оранжево-красный. Исследования этого токсина были начаты после того, как в Польше в 1952-1955 гг. и в 1957 г. было зарегистрировано около 130 случаев отравления этим грибом, причем 19 из них со смертельным исходом. Первые симптомы отравления проявляются не ранее, чем через 2 дня, иногда и через 2 недели (до 17 дней, поэтому при первых случаях отравления им в 50-х годах часто даже не подозревали, что это отравление грибами, а предполагали инфекционную болезнь. Паутинник оранжево-красный ядовит для людей и животных. Его токсин часто в первую очередь поражает почки. Токсин состоит из двух фракций, различающихся по характеру действия на организм: одна из них вызывает нарушение дыхания и асфиксию, а другая — двигательный паралич. Обе фракции отличаются очень высокой летальностью действия, но даже при введении животным высоких их концентраций первые симптомы отравления наблюдались только через 48 ч.
Розовопластинник весенний — один из самых ранних ядовитых грибов, появляется он в апреле на опушках леса, в садах и скверах
Есть еще один токсин, по продолжительности латентного периода даже превосходящий токсины бледной поганки. Его содержит паутинник оранжево-красный. Исследования этого токсина были начаты после того, как в Польше в 1952-1955 гг. и в 1957 г. было зарегистрировано около 130 случаев отравления этим грибом, причем 19 из них со смертельным исходом. Первые симптомы отравления проявляются не ранее, чем через 2 дня, иногда и через 2 недели (до 17 дней, поэтому при первых случаях отравления им в 50-х годах часто даже не подозревали, что это отравление грибами, а предполагали инфекционную болезнь. Паутинник оранжево-красный ядовит для людей и животных. Его токсин часто в первую очередь поражает почки. Токсин состоит из двух фракций, различающихся по характеру действия на организм: одна из них вызывает нарушение дыхания и асфиксию, а другая — двигательный паралич. Обе фракции отличаются очень высокой летальностью действия, но даже при введении животным высоких их концентраций первые симптомы отравления наблюдались только через 48 ч.
Первая помощь при грибных отравлениях
При грибных отравлениях необходимо срочно обеспечить больному квалифицированную медицинскую помощь. Если есть подозрения, что это отравление бледной поганкой или другими ядовитыми грибами, больного нужно немедленно отправить в больницу. До прихода врача ему оказывают некоторые меры первой помощи. Прежде всего больного рекомендуется уложить в постель, так как при многих грибных отравлениях наблюдаются нарушения сердечной деятельности и кровообращения. К ногам и на живот следует положить грелку. Ни в коем случае нельзя прибегать к мерам самолечения! Больному можно давать только небольшими порциями холодную подсоленную воду, а также для укрепления сердечной деятельности крепкий чай или кофе, молоко, в известной мере нейтрализующее яды. Нельзя давать спиртных напитков, так как они ускоряют всасывание токсинов. Нужно помнить, что успех лечения при грибных отравлениях зависит прежде всего от того, насколько быстро будет оказана врачебная помощь, так как у многих токсинов, наиболее опасных для жизни, длительный латентный период, и при появлении симптомов каждая упущенная минута может стоить больному жизни. Для определения причин отравления необходимо оставить до прихода врача остатки несъеденных грибов и их очистки. Это позволит скорее выяснить, какие токсины вызвали отравление, и скорее принять меры, необходимые именно при данном отравлении.Как избежать отравления грибами
Главное средство защиты от грибных отравлений — их профилактика. Нельзя собирать и употреблять в пищу незнакомые грибы, а также те, для которых в справочниках указано, что их съедобные качества неизвестны, нужно твердо помнить, что отличить съедобные грибы от ядовитых можно только по совокупности их внешних признаков, характерных для того или иного вида. Довольно широко распространенное мнение о том, что существуют надежные народные методы, по которым можно различить ядовитые и неядовитые грибы, в корне неверно. Именно при использовании таких "методов" часто и происходят тяжелые отравления! Считают, например, что ядовитые грибы вызывают потемнение луковицы или серебряных предметов, например ложки, если опустить их в посуду, где варятся грибы. Это ложное представление! Указанные явления имеют научное объяснение, но никак не связаны с содержанием токсинов в грибах. Ошибочно также мнение, что в ядовитых грибах не развиваются "черви" (личинки грибных мух и комариков), что их не трогают слизни и что эти грибы всегда имеют неприятные запах и вкус. Известно, что многие ядовитые грибы, в том числе и бледная поганка, отличаются приятным грибным запахом. Крайне вредны представления, что токсины содержатся в грибах только на поздних стадиях их развития или только в определенных их частях, например в кожице шляпки, и если собирать только молодые грибы или снять с них кожицу, их можно спокойно употреблять в пищу. Многочисленные исследования показали: что наиболее опасные токсины содержатся в грибах на всех стадиях развития их плодовых тел и во всех их частях. Вот почему единственный способ надежной профилактики грибных отравлений — это умение различать основные съедобные и ядовитые грибы по внешним признакам и никогда не есть незнакомые грибы.Съедобные грибы
 Съедобные грибы — резерв белковой пищи
Исторически сложилось так, что в России, как ни в одной стране, грибы стали традиционным национальным блюдом, причем сушеные и соленые издавна были предметом экспорта во многие страны. Любят у нас грибы и сейчас, причем ряды грибников все больше и больше пополняются городским населением. Теперь уже стали обычными у нас специальные поезда в пригородные грибные места, выезды в лес по грибы на автобусах, целыми коллективами, обилие легковых автомашин, ожидающих своих владельцев на обочинах проселочных дорог и шоссе. К сожалению, еще можно порой видеть глубокую колею прямо на лесной подстилке — колыбели грибов, а легковой автомобиль под деревом на поляне, где быть ему не положено.
Секрет популярности съедобных грибов не только в их своеобразных вкусовых качествах, но, безусловно, и в самом процессе их сбора.
Съедобные грибы — резерв белковой пищи
Исторически сложилось так, что в России, как ни в одной стране, грибы стали традиционным национальным блюдом, причем сушеные и соленые издавна были предметом экспорта во многие страны. Любят у нас грибы и сейчас, причем ряды грибников все больше и больше пополняются городским населением. Теперь уже стали обычными у нас специальные поезда в пригородные грибные места, выезды в лес по грибы на автобусах, целыми коллективами, обилие легковых автомашин, ожидающих своих владельцев на обочинах проселочных дорог и шоссе. К сожалению, еще можно порой видеть глубокую колею прямо на лесной подстилке — колыбели грибов, а легковой автомобиль под деревом на поляне, где быть ему не положено.
Секрет популярности съедобных грибов не только в их своеобразных вкусовых качествах, но, безусловно, и в самом процессе их сбора.
Грибы как продукт питания
Грибы содержат многие полезные для организма человека питательные вещества. Однако для оценки грибов как пищевого продукта необходимо учитывать также их урожайность, распространение, размеры плодовых тел, вкусовые качества и др. Дело в том, что хозяйственную ценность представляют только те виды, которые имеют широкий ареал, более или менее устойчивую урожайность, обилие плодовых тел достаточно крупного размера с развитой мякотью и хорошими вкусовыми качествами. Редкие грибы, появляющиеся спорадически и в небольших количествах, как бы вкусны и питательны они ни были, в счет идти не могут, имеют случайное значение. Белый гриб, подберезовик или подосиновик, повсеместно встречающиеся на многих континентах и почти на всей территории нашей страны, могут рассматриваться как весьма ценное подспорье для питания, а цезарский гриб, довольно редкий в буковых лесах, при всех его пищевых и вкусовых достоинствах никакого экономического интереса не представляет. При оценке съедобных грибов существенное значение имеют их размеры. Многие шляпочные грибы по своим вкусовым и питательным качествам могли бы служить хорошим пищевым продуктом, например негниючники, мицены, денежки и др., но они настолько малы, особенно если принять во внимание большое содержание в них воды, что собирать их нецелесообразно. Вопрос о съедобности различных грибов до сих пор еще вызывает серьезные споры не только между микологами разных стран, но и между людьми из разных местностей и даже различными группами населения одной и той же местности. Насколько могут быть различны взгляды на хозяйственную ценность отдельных грибов свидетельствуют такие, например, факты. В ГДР, ФРГ и Франции многие виды сыроежек считаются ядовитыми, а у нас все виды этого рода употребляются в пищу, причем 12 из них разрешены к заготовке государственными и кооперативными организациями и включены в стандарты на грибную продукцию. В некоторых странах Западной Европы и в первую очередь в Швейцарии население никогда не использует белые грибы, которые растут там в изобилии. В ряде мусульманских стран собирать и есть грибы вообще считается грехом, поскольку это запрещено кораном. В Башкирии и ряде прилегающих к ней районах не собирают съедобный гигантский сморчок. В Узбекистане до последнего времени не собирали степные белые грибы, шампиньоны и грибы-зонтики, в Бурятии — белые, а в Забайкалье собирают только рыжики и грузди. До последнего времени в центральных областях европейской части СССР, особенно в городах, с предубеждением относились к шампиньону обыкновенному, растущему на лугах, в скверах и на бульварах. Лишь в последнее время эти вкусные грибы стали собирать. Обходят сборщики и такие очень вкусные и довольно часто встречающиеся грибы, как строфарию сине-зеленую, мокруху еловую, говорушки серую и ворончатую и др. Основным принципом, которым руководствуются при отнесении того или иного вида гриба к группе съедобных, является то, что данный вид считается съедобным у местного населения или приводится как съедобный в литературе. Категории, или сорта, грибов. В санитарных правилах по заготовке, переработке и продаже грибов 1981 г. дан перечень и подробное описание съедобных грибов, разрешенных к заготовке и включенных в стандарты на грибную продукцию. Всего названо 54 вида грибов, причем по своей пищевой ценности они разбиты на четыре категории. Грибники
По отечественным стандартам, к первой, самой высокой, категории относят белый гриб, груздь настоящий, рыжик настоящий, или деликатесный. По литературным источникам (Васильков Б. П. Съедобные и ядовитые грибы. Л., 1948), к грибам первой категории относятся четыре формы белого гриба (березовый, дубовый, еловый и сосновый), груздь настоящий и две формы рыжиков (сосновый и еловый).
Грибники
По отечественным стандартам, к первой, самой высокой, категории относят белый гриб, груздь настоящий, рыжик настоящий, или деликатесный. По литературным источникам (Васильков Б. П. Съедобные и ядовитые грибы. Л., 1948), к грибам первой категории относятся четыре формы белого гриба (березовый, дубовый, еловый и сосновый), груздь настоящий и две формы рыжиков (сосновый и еловый).
 Мокруха еловая
Ко второй категории съедобных грибов относят масленки зернистый и поздний, подосиновики желто-бурый и красно-бурый, шампиньоны обыкновенный и двуспоровый (культивируемый), подгруздок белый и груздь желтый (в литературе называют 11 видов и 18 форм грибов, относящихся по своей хозяйственной ценности ко второй категории).
Мокруха еловая
Ко второй категории съедобных грибов относят масленки зернистый и поздний, подосиновики желто-бурый и красно-бурый, шампиньоны обыкновенный и двуспоровый (культивируемый), подгруздок белый и груздь желтый (в литературе называют 11 видов и 18 форм грибов, относящихся по своей хозяйственной ценности ко второй категории).
 Зонтик золотистый, или чешуйчатка травяная
Наибольшее число видов грибов принадлежит к третьей категории — 28, в том числе сморчки и строчки, лисичка обыкновенная, моховик, подберезовик, польский гриб, опенок осенний, валуй, сыроежки, груздь осиновый, молочай, волнушка.
К четвертой категории относятся грибы с грубой мякотью — скрипица, серушка, грузди перечный и черный, гладыш, горькушка, подгруздок черный и некоторые другие.
В справочниках часто можно прочесть, что съедобность данного гриба неизвестна.К таким грибам относят, в частности, говорушку рыже-бурую, рядовку желто-бурую, коллибию пятнистую, зонтики гребенчатый и острочешуйчатый и др. Очевидно, что такие грибы нельзя употреблять в пищу. Наконец, среди всех категорий можно выделить группу, условно съедобных грибов, которые можно есть только после определенной предварительной обработки. К ним в первую очередь относятся сморчки и строчки. Перед употреблением их необходимо отваривать 15-20 мин в большом количестве воды, а затем тщательно промыть холодной водой.
К условно съедобным можно отнести и некоторые млечники, обладающие очень едким соком, а также виды сыроежек с очень неприятной едкой или горькой мякотью. Эти грибы необходимо вымачивать (сыроежки и валуи) или отваривать (волнушки, горькушки, скрипицы, сыроежки пищевую и сереющую), после чего они обычно идут в засол.
Условно съедобна свинушка толстая, причем по отношению к этому грибу у людей существует индивидуальная чувствительность: одни употребляют его в пищу без неприятных последствий, другие не переносят вообще. В этом грибе содержится вещество пока неизвестной природы, оказывающее на некоторых людей отрицательное влияние, однако при варке свинушки оно полностью удаляется и после этого ее можно мариновать и солить.
Некоторые грибы можно употреблять только при определенном способе приготовления. Сыроежки пищевую, жгуче-едкую, подгруздок черный, валуй, белянку, груздь перечный, серушку, горькушку едят только солеными, так как при засоле исчезает их едкий вкус, и они уже не могут вызвать раздражение желудочно-кишечного тракта.
Обычно в каждом районе, области и даже крае собирают от 6 до 15 наиболее широко распространенных и известных вида, знания о которых передаются жителями вместе с местным названием гриба из поколения в поколение. Например, в Ярославской обл. широко собирают растущие в сосновых лесах коллибию масляную и говорушку булавоногую, которую здесь называют белянка. В других районах страны эти малоизвестные съедобные грибы почти не собирают. А на Кавказе местное население очень любит растущую на буках вешенку, предпочитая ее даже подосиновикам, причем у вешенки здесь тоже есть местное название — "чинарики".
Зонтик золотистый, или чешуйчатка травяная
Наибольшее число видов грибов принадлежит к третьей категории — 28, в том числе сморчки и строчки, лисичка обыкновенная, моховик, подберезовик, польский гриб, опенок осенний, валуй, сыроежки, груздь осиновый, молочай, волнушка.
К четвертой категории относятся грибы с грубой мякотью — скрипица, серушка, грузди перечный и черный, гладыш, горькушка, подгруздок черный и некоторые другие.
В справочниках часто можно прочесть, что съедобность данного гриба неизвестна.К таким грибам относят, в частности, говорушку рыже-бурую, рядовку желто-бурую, коллибию пятнистую, зонтики гребенчатый и острочешуйчатый и др. Очевидно, что такие грибы нельзя употреблять в пищу. Наконец, среди всех категорий можно выделить группу, условно съедобных грибов, которые можно есть только после определенной предварительной обработки. К ним в первую очередь относятся сморчки и строчки. Перед употреблением их необходимо отваривать 15-20 мин в большом количестве воды, а затем тщательно промыть холодной водой.
К условно съедобным можно отнести и некоторые млечники, обладающие очень едким соком, а также виды сыроежек с очень неприятной едкой или горькой мякотью. Эти грибы необходимо вымачивать (сыроежки и валуи) или отваривать (волнушки, горькушки, скрипицы, сыроежки пищевую и сереющую), после чего они обычно идут в засол.
Условно съедобна свинушка толстая, причем по отношению к этому грибу у людей существует индивидуальная чувствительность: одни употребляют его в пищу без неприятных последствий, другие не переносят вообще. В этом грибе содержится вещество пока неизвестной природы, оказывающее на некоторых людей отрицательное влияние, однако при варке свинушки оно полностью удаляется и после этого ее можно мариновать и солить.
Некоторые грибы можно употреблять только при определенном способе приготовления. Сыроежки пищевую, жгуче-едкую, подгруздок черный, валуй, белянку, груздь перечный, серушку, горькушку едят только солеными, так как при засоле исчезает их едкий вкус, и они уже не могут вызвать раздражение желудочно-кишечного тракта.
Обычно в каждом районе, области и даже крае собирают от 6 до 15 наиболее широко распространенных и известных вида, знания о которых передаются жителями вместе с местным названием гриба из поколения в поколение. Например, в Ярославской обл. широко собирают растущие в сосновых лесах коллибию масляную и говорушку булавоногую, которую здесь называют белянка. В других районах страны эти малоизвестные съедобные грибы почти не собирают. А на Кавказе местное население очень любит растущую на буках вешенку, предпочитая ее даже подосиновикам, причем у вешенки здесь тоже есть местное название — "чинарики".
Заготовка и хранение грибов
 Заготовка и хранение грибов
Грибы могут быть использованы свежими (в супах, жареном виде, соусах и т. д.), а также солеными, сушеными или маринованными, причем определенным видам обычно соответствуют и определенные способы использования. Белый гриб, подберезовик, масленок можно употреблять свежими, сушеными, маринованными и солеными. Грузди, волнушки, горькушки и другие млечники, имеющие едкий вкус, годны только для соления, так как едкость исчезает лишь при посоле.
В качестве общего правила, сложившегося веками, большинство видов съедобных пластинчатых грибов употребляется в пищу солеными, а трубчатые — свежими, сушеными или маринованными. Малоценные виды обычно впрок не заготавливают, а используют только свежими, причем желательно это делать в день их сбора.
Заготовка и хранение грибов
Грибы могут быть использованы свежими (в супах, жареном виде, соусах и т. д.), а также солеными, сушеными или маринованными, причем определенным видам обычно соответствуют и определенные способы использования. Белый гриб, подберезовик, масленок можно употреблять свежими, сушеными, маринованными и солеными. Грузди, волнушки, горькушки и другие млечники, имеющие едкий вкус, годны только для соления, так как едкость исчезает лишь при посоле.
В качестве общего правила, сложившегося веками, большинство видов съедобных пластинчатых грибов употребляется в пищу солеными, а трубчатые — свежими, сушеными или маринованными. Малоценные виды обычно впрок не заготавливают, а используют только свежими, причем желательно это делать в день их сбора.
 Польский гриб можно использовать как в свежем, так и в сушеном виде
В связи с тем, что в различных районах нашей страны ассортимент дикорастущих грибов различен, а свойства одноименных видов могут несколько меняться, в разных союзных республиках могут быть составлены по согласованию с органами государственного санитарного надзора республики несколько измененные списки съедобных грибов, рекомендованных к сбору и заготовке.
В соответствии с санитарными правилами сушить разрешается следующие виды грибов:
• белые,
• подосиновики,
• подберезовики,
• маслята,
• моховики,
• польский гриб,
• козляк и
• сморчковые грибы, причем последние разрешается реализовать только после 1-2 мес высушивания (правила разрешают сушку также лисичек и осенних опят, предназначенных для экспорта).
Сушка грибов — один из самых распространенных и удобных способов переработки грибов, потому что сушеные грибы не только хорошо сохраняются длительное время, но к тому же не требуют громоздкой тары, их легко упаковывать и перевозить. Кроме того, при сушке грибы сохраняют свои ценные питательные качества, а также вкус и аромат, чего нельзя достигнуть никаким иным способом их переработки для длительного хранения.
Польский гриб можно использовать как в свежем, так и в сушеном виде
В связи с тем, что в различных районах нашей страны ассортимент дикорастущих грибов различен, а свойства одноименных видов могут несколько меняться, в разных союзных республиках могут быть составлены по согласованию с органами государственного санитарного надзора республики несколько измененные списки съедобных грибов, рекомендованных к сбору и заготовке.
В соответствии с санитарными правилами сушить разрешается следующие виды грибов:
• белые,
• подосиновики,
• подберезовики,
• маслята,
• моховики,
• польский гриб,
• козляк и
• сморчковые грибы, причем последние разрешается реализовать только после 1-2 мес высушивания (правила разрешают сушку также лисичек и осенних опят, предназначенных для экспорта).
Сушка грибов — один из самых распространенных и удобных способов переработки грибов, потому что сушеные грибы не только хорошо сохраняются длительное время, но к тому же не требуют громоздкой тары, их легко упаковывать и перевозить. Кроме того, при сушке грибы сохраняют свои ценные питательные качества, а также вкус и аромат, чего нельзя достигнуть никаким иным способом их переработки для длительного хранения.
 В подобных условиях грибы можно сушить и около костра
В домашних условиях грибы сушат при температуре 50-80oС в русской печи с приоткрытыми трубой и печной заслонкой для хорошей циркуляции воздуха и в духовке или плите на специально смонтированных сушилках или нанизанными на деревянные спицы, крепкую нитку, шнурок.
В подобных условиях грибы можно сушить и около костра
В домашних условиях грибы сушат при температуре 50-80oС в русской печи с приоткрытыми трубой и печной заслонкой для хорошей циркуляции воздуха и в духовке или плите на специально смонтированных сушилках или нанизанными на деревянные спицы, крепкую нитку, шнурок.
 Приспособление для сушки грибов
Приготовленные для сушки грибы не моют (так как после мытья они чернеют). Для ускорения сушки крупные грибы можно нарезать вдоль на тонкие ломтики и сушить такую грибную лапшу на противнях и ситах, рассыпав ее тонким слоем и время от времени перемешивая. Сушка грибов производится в несколько приемов и считается законченной, если грибы слегка гнутся, ломаются, но не крошатся. Высушенные грибы хранят в марлевых мешочках в сухом месте. Пересушенные, крошащиеся, но не сгоревшие грибы рекомендуется истолочь или смолоть в порошок, который с успехом можно использовать для приготовления соусов и подлив. Хранить грибной порошок следует в широкогорлых стеклянных банках или бутылках плотно закрытых крышками или пробками.
В домашних условиях небольшое количество грибов можно высушить над горячей плитой, у горячей стенки русской или голландской печи нанизанными на шпагат. В жаркие, безоблачные летние дни можно высушить грибы на солнце, для этого следует сделать специальную подставку с металлическими стержнями (шомполами), нанизанные на стержни грибы разместить на подставке и выставить на солнцепек. При этом их следует прикрыть марлей для предохранения от пыли и мух. С наступлением пасмурной погоды грибы досушивают в печке, духовке или над горячей плитой.
Сушка сморчков и строчков имеет свои особенности, и их необходимо знать. Прежде всего следует помнить, что для сушки пригодны только молодые сморчки и строчки. Перед сушкой их тщательно перетирают увлажненной чистой тряпочкой или полотенцем, из складок шляпок удаляют частицы земли и песка, а ножку коротко обрезают. Сушат эти грибы на воздухе или в хорошо проветриваемом помещении. Предварительно их нанизывают на прочную нитку, желательно суровую, прокалывая иглой в ножку у основания шляпки, причем нанизывать следует не очень плотно, так как в пасмурную и прохладную погоду в местах соприкосновения появляется плесень. Досушивают грибы в русской печи, но только на легком жару. В печах сушить сморчки и строчки не рекомендуется, поскольку они чернеют, теряют форму и присущий им аромат. Хорошо высушенные грибы сохраняют свою упругость и не ломаются. Повторяем, что употреблять сморчки и строчки в пищу можно только через 1-2 мес после сушки.
Прекрасный способ консервации грибов — замораживание. Правда, у нас этот процесс еще не имеет широкого применения и теоретически недостаточно исследован. Специалисты из Скандинавских стран, где этот способ хранения грибов приобретает все большее значение, утверждают, что для замораживания пригодны все виды грибов, причем замораживать можно как целые грибы, так и нарезанные или одни шляпки. Замораживать можно и жареные грибы, причем это выгодно, так как они занимают значительно меньший объем, чем свежезамороженные, и из них значительно быстрее можно приготовить блюдо. При жарке грибов предпочтительнее использовать сливочное, а не растительное масло. Степень сохранности жареных грибов при замораживании ниже, чем у свежезамороженных, но тем не менее они отлично сохраняются минимум 3-4 мес. Очень хорошо сохраняются в замороженном виде тушеные грибы, приготовленные в собственном соку: для тушения с последующим замораживанием предпочтительнее трубчатые грибы. Готовить блюда следует только из полностью оттаявших грибов.
Свежие грибы, замороженные при температуре — 28oС и полуфабрикаты, замороженные при температуре — 18- 20oС, сохраняются 6-12 мес. Имеется опыт замораживания свежих грибов в морозильных камерах холодильников при температуре -18oС, такие грибы отлично сохраняются до 6-8 мес.
Засолка — один из древнейших и общепринятых способов консервирования грибов. У нас обычно солят грибы, имеющие горький сок, специфические запах или вкус, — грузди, подгруздки, волнушки, валуй, некоторые сыроежки и др. Не следует солить зрелые трубчатые трибы — при варке они становятся мягкими, слизистыми, дряблыми. Существует три вида засолки:
• горячая,
• холодная,
• сухая.
При солении горячим способом подготовленные промытые грибы отваривают в кипящей подсоленной воде (2 столовые ложки соли на 1 л воды), потом выкладывают их на решето или на металлическое луженое сито и дают воде стечь. Когда грибы остынут, их укладывают в деревянную, глиняную или эмалированную емкость и солят из расчета 30 г соли на 1 кг грибов (3% от массы грибов). Для аромата добавляют немного укропа, чеснока, лавровый лист, душистый перец, гвоздику и листья смородины.
После укладки грибы прикрывают деревянным кружком, на который кладут небольшой гнет.
Сроки варки грибов, предназначенных для засола, различны. Грузди, подгруздки, серушки и сыроежки варят 5-10, а лисички, опенки и свинушки 20-25 мин. Волнушки и белянки обычно ошпаривают кипятком и держат в нем около получаса, после чего горечь почти исчезает. С валуями и скрипицами поступают несколько иначе. Эти грибы сначала в течение 2-3 суток отмачивают (с ежедневной двукратной сменой воды), а затем отваривают в течение 30 мин.
Приспособление для сушки грибов
Приготовленные для сушки грибы не моют (так как после мытья они чернеют). Для ускорения сушки крупные грибы можно нарезать вдоль на тонкие ломтики и сушить такую грибную лапшу на противнях и ситах, рассыпав ее тонким слоем и время от времени перемешивая. Сушка грибов производится в несколько приемов и считается законченной, если грибы слегка гнутся, ломаются, но не крошатся. Высушенные грибы хранят в марлевых мешочках в сухом месте. Пересушенные, крошащиеся, но не сгоревшие грибы рекомендуется истолочь или смолоть в порошок, который с успехом можно использовать для приготовления соусов и подлив. Хранить грибной порошок следует в широкогорлых стеклянных банках или бутылках плотно закрытых крышками или пробками.
В домашних условиях небольшое количество грибов можно высушить над горячей плитой, у горячей стенки русской или голландской печи нанизанными на шпагат. В жаркие, безоблачные летние дни можно высушить грибы на солнце, для этого следует сделать специальную подставку с металлическими стержнями (шомполами), нанизанные на стержни грибы разместить на подставке и выставить на солнцепек. При этом их следует прикрыть марлей для предохранения от пыли и мух. С наступлением пасмурной погоды грибы досушивают в печке, духовке или над горячей плитой.
Сушка сморчков и строчков имеет свои особенности, и их необходимо знать. Прежде всего следует помнить, что для сушки пригодны только молодые сморчки и строчки. Перед сушкой их тщательно перетирают увлажненной чистой тряпочкой или полотенцем, из складок шляпок удаляют частицы земли и песка, а ножку коротко обрезают. Сушат эти грибы на воздухе или в хорошо проветриваемом помещении. Предварительно их нанизывают на прочную нитку, желательно суровую, прокалывая иглой в ножку у основания шляпки, причем нанизывать следует не очень плотно, так как в пасмурную и прохладную погоду в местах соприкосновения появляется плесень. Досушивают грибы в русской печи, но только на легком жару. В печах сушить сморчки и строчки не рекомендуется, поскольку они чернеют, теряют форму и присущий им аромат. Хорошо высушенные грибы сохраняют свою упругость и не ломаются. Повторяем, что употреблять сморчки и строчки в пищу можно только через 1-2 мес после сушки.
Прекрасный способ консервации грибов — замораживание. Правда, у нас этот процесс еще не имеет широкого применения и теоретически недостаточно исследован. Специалисты из Скандинавских стран, где этот способ хранения грибов приобретает все большее значение, утверждают, что для замораживания пригодны все виды грибов, причем замораживать можно как целые грибы, так и нарезанные или одни шляпки. Замораживать можно и жареные грибы, причем это выгодно, так как они занимают значительно меньший объем, чем свежезамороженные, и из них значительно быстрее можно приготовить блюдо. При жарке грибов предпочтительнее использовать сливочное, а не растительное масло. Степень сохранности жареных грибов при замораживании ниже, чем у свежезамороженных, но тем не менее они отлично сохраняются минимум 3-4 мес. Очень хорошо сохраняются в замороженном виде тушеные грибы, приготовленные в собственном соку: для тушения с последующим замораживанием предпочтительнее трубчатые грибы. Готовить блюда следует только из полностью оттаявших грибов.
Свежие грибы, замороженные при температуре — 28oС и полуфабрикаты, замороженные при температуре — 18- 20oС, сохраняются 6-12 мес. Имеется опыт замораживания свежих грибов в морозильных камерах холодильников при температуре -18oС, такие грибы отлично сохраняются до 6-8 мес.
Засолка — один из древнейших и общепринятых способов консервирования грибов. У нас обычно солят грибы, имеющие горький сок, специфические запах или вкус, — грузди, подгруздки, волнушки, валуй, некоторые сыроежки и др. Не следует солить зрелые трубчатые трибы — при варке они становятся мягкими, слизистыми, дряблыми. Существует три вида засолки:
• горячая,
• холодная,
• сухая.
При солении горячим способом подготовленные промытые грибы отваривают в кипящей подсоленной воде (2 столовые ложки соли на 1 л воды), потом выкладывают их на решето или на металлическое луженое сито и дают воде стечь. Когда грибы остынут, их укладывают в деревянную, глиняную или эмалированную емкость и солят из расчета 30 г соли на 1 кг грибов (3% от массы грибов). Для аромата добавляют немного укропа, чеснока, лавровый лист, душистый перец, гвоздику и листья смородины.
После укладки грибы прикрывают деревянным кружком, на который кладут небольшой гнет.
Сроки варки грибов, предназначенных для засола, различны. Грузди, подгруздки, серушки и сыроежки варят 5-10, а лисички, опенки и свинушки 20-25 мин. Волнушки и белянки обычно ошпаривают кипятком и держат в нем около получаса, после чего горечь почти исчезает. С валуями и скрипицами поступают несколько иначе. Эти грибы сначала в течение 2-3 суток отмачивают (с ежедневной двукратной сменой воды), а затем отваривают в течение 30 мин.
 Серушка, как и большинство других млечников, годится в основном в засол
При горячем солении грибы скорее становятся готовыми к употреблению.
Сыроежки, например, можно есть уже через сутки — двое после посола.
Холодным способом засаливают рыжики, некоторые сыроежки и другие грибы, не имеющие едкого вкуса, причем сразу же после очистки этих грибов и мытья. Грибы с едким вкусом — некоторые грузди, волнушки, гладыши и сыроежки — перед засолкой необходимо отмачивать не менее 24 ч, а валуй, горькушку, черный груздь отмачивают до 48 ч. После этого едкий вкус значительно уменьшается, окончательно он исчезает только через 1-1,5 мес после засола. После отмачивания воду сливают, грибы перекладывают на решето, тщательно промывают холодной водой и закладывают в чистую тару — бочку, эмалированную или глиняную посуду — обязательно шляпками вниз, слоем в 5-7 см. Каждый слой пересыпают хорошей чистой, мелкого помола солью. Дальше поступают так же, как при горячем солении. Хранить засоленные грибы следует в хорошо проветриваемых помещениях, на складах или в подвалах при температуре 1-2oС. В зимнее время грибы следует предохранять от замерзания.
По санитарным правилам, отварные и соленые грибы, расфасованные в бочки, могут храниться при температуре 0-2oС не более 6 мес, причем в процессе хранения они должны подвергаться периодическому осмотру с участием специалиста-товароведа.
В домашних условиях соленые грибы в банках можно хранить в холодильнике, в погребе или в холодное время прикрытыми на балконе, следя за тем, чтобы они не замерзли, иначе вкусовые их качества снижаются.
Сухому засолу подвергаются только рыжики. Перед засолом их не вымачивают и даже не моют. Лучше их только обдуть, обобрать с них сор, травинки и хвою и протереть чистой тряпкой, удаляя остатки земли и мусора. Если рыжиков много, бочку следует хорошо пропарить, а если немного, то для засола можно использовать хорошо вымытые эмалированное ведро или кастрюлю. В посуду рыжики укладывают слоем около 6 см толщиной, обязательно шляпками вниз. Каждый слой пересыпают солью из расчета 30 г соли на 1 кг грибов и покрывают грибы чистой тканью (марлей), на которую кладут хорошо промытый и ошпаренный кипятком деревянный кружок, а на него гнет. Через несколько дней грибы дадут сок, причем значительно уплотнятся и осядут. По мере оседания в посуду можно добавлять свежие грибы, пересыпая их солью, так до тех пор, пока дальнейшее оседание грибов не прекратится. При засоле рыжиков сухим способом не рекомендуется добавлять в рассол пряности, так как от них грибы темнеют. Посоленные таким способом грибы можно есть уже через 10 дней.
При хорошем урожае грибов можно рекомендовать засаливать их по видам, что позволит разным по вкусу грибам сохранить свои природные вкусовые качества.
Маринование грибов — это консервирование их с применением уксусной или лимонной кислоты и специй. Для маринования отбирают мелкие молодые плотные белые грибы, подосиновики, подберезовики, маслята, моховики, рыжики, опенки, лисички, рядовки и другие грибы, не имеющие едкого вкуса. Маринуют каждый вид грибов отдельно, причем только шляпки, предварительно рассортированные по размерам.
Моховики перед варкой обдают кипятком и держат в этой воде 5-10 мин, после чего промывают холодной водой — это сохраняет маринад от почернения. Ножки белых грибов, подосиновиков и подберезовиков маринуют отдельно от шляпок. Лисички, валуи и свинушки перед маринованием 25-30 мин отваривают в подсоленной воде, затем откидывают на решето и промывают. Вторично эти грибы варят уже в маринаде со специями.
При мариновании грибов жизнедеятельность микроорганизмов подавляется высокой температурой (при варке), а затем действием уксусной кислоты и поваренной соли.
Когда грибов немного, их маринуют разными способами: варят подготовленные и вымытые грибы вместе с маринадом или варят отдельно маринад и грибы, а потом их соединяют. В некоторых случаях для варки опускают грибы в кипящую воду, в других случаях сначала заливают грибы холодной водой и доводят до кипения, причем первую воду с небольшим количеством соли, в которой варились грибы, выливают и доваривают их во второй воде.
Серушка, как и большинство других млечников, годится в основном в засол
При горячем солении грибы скорее становятся готовыми к употреблению.
Сыроежки, например, можно есть уже через сутки — двое после посола.
Холодным способом засаливают рыжики, некоторые сыроежки и другие грибы, не имеющие едкого вкуса, причем сразу же после очистки этих грибов и мытья. Грибы с едким вкусом — некоторые грузди, волнушки, гладыши и сыроежки — перед засолкой необходимо отмачивать не менее 24 ч, а валуй, горькушку, черный груздь отмачивают до 48 ч. После этого едкий вкус значительно уменьшается, окончательно он исчезает только через 1-1,5 мес после засола. После отмачивания воду сливают, грибы перекладывают на решето, тщательно промывают холодной водой и закладывают в чистую тару — бочку, эмалированную или глиняную посуду — обязательно шляпками вниз, слоем в 5-7 см. Каждый слой пересыпают хорошей чистой, мелкого помола солью. Дальше поступают так же, как при горячем солении. Хранить засоленные грибы следует в хорошо проветриваемых помещениях, на складах или в подвалах при температуре 1-2oС. В зимнее время грибы следует предохранять от замерзания.
По санитарным правилам, отварные и соленые грибы, расфасованные в бочки, могут храниться при температуре 0-2oС не более 6 мес, причем в процессе хранения они должны подвергаться периодическому осмотру с участием специалиста-товароведа.
В домашних условиях соленые грибы в банках можно хранить в холодильнике, в погребе или в холодное время прикрытыми на балконе, следя за тем, чтобы они не замерзли, иначе вкусовые их качества снижаются.
Сухому засолу подвергаются только рыжики. Перед засолом их не вымачивают и даже не моют. Лучше их только обдуть, обобрать с них сор, травинки и хвою и протереть чистой тряпкой, удаляя остатки земли и мусора. Если рыжиков много, бочку следует хорошо пропарить, а если немного, то для засола можно использовать хорошо вымытые эмалированное ведро или кастрюлю. В посуду рыжики укладывают слоем около 6 см толщиной, обязательно шляпками вниз. Каждый слой пересыпают солью из расчета 30 г соли на 1 кг грибов и покрывают грибы чистой тканью (марлей), на которую кладут хорошо промытый и ошпаренный кипятком деревянный кружок, а на него гнет. Через несколько дней грибы дадут сок, причем значительно уплотнятся и осядут. По мере оседания в посуду можно добавлять свежие грибы, пересыпая их солью, так до тех пор, пока дальнейшее оседание грибов не прекратится. При засоле рыжиков сухим способом не рекомендуется добавлять в рассол пряности, так как от них грибы темнеют. Посоленные таким способом грибы можно есть уже через 10 дней.
При хорошем урожае грибов можно рекомендовать засаливать их по видам, что позволит разным по вкусу грибам сохранить свои природные вкусовые качества.
Маринование грибов — это консервирование их с применением уксусной или лимонной кислоты и специй. Для маринования отбирают мелкие молодые плотные белые грибы, подосиновики, подберезовики, маслята, моховики, рыжики, опенки, лисички, рядовки и другие грибы, не имеющие едкого вкуса. Маринуют каждый вид грибов отдельно, причем только шляпки, предварительно рассортированные по размерам.
Моховики перед варкой обдают кипятком и держат в этой воде 5-10 мин, после чего промывают холодной водой — это сохраняет маринад от почернения. Ножки белых грибов, подосиновиков и подберезовиков маринуют отдельно от шляпок. Лисички, валуи и свинушки перед маринованием 25-30 мин отваривают в подсоленной воде, затем откидывают на решето и промывают. Вторично эти грибы варят уже в маринаде со специями.
При мариновании грибов жизнедеятельность микроорганизмов подавляется высокой температурой (при варке), а затем действием уксусной кислоты и поваренной соли.
Когда грибов немного, их маринуют разными способами: варят подготовленные и вымытые грибы вместе с маринадом или варят отдельно маринад и грибы, а потом их соединяют. В некоторых случаях для варки опускают грибы в кипящую воду, в других случаях сначала заливают грибы холодной водой и доводят до кипения, причем первую воду с небольшим количеством соли, в которой варились грибы, выливают и доваривают их во второй воде.
 Малоизвестные съедобные грибы: 1 — мокруха пурпуровая; 2 — коллибия лесолюбивая; 3 — лисичка серая; 4 — коллибия масляная; 5 — зонтик краснеющий; 6 — строфария сине-зеленая; 7 — лаковица розовая
На варочных пунктах, где заготавливают большое количество грибов, строго придерживаются определенной рецептуры.
В состав маринада, предназначенного для белых грибов, входят следующие компоненты (в граммах на 1 кг грибов): воды 120-140; соли ("Экстра" или помола № 0) 40-45; уксусной эссенции 80%-ной 6; лимонной кислоты 0,3; лаврового листа 0,2; перца душистого, гвоздики, корицы и бадьяна по 0,1. Состав маринада для рыжиков, валуев, подберезовиков, подосиновиков, маслят, лисичек и опенков сходен, однако в него не добавляют лимонную кислоту, гвоздику, корицу и бадьян, а уксуса добавляют вдвое меньше.
Варить грибы лучше всего в эмалированной посуде, причем для повышения качества их лучше опустить сразу в кипящую воду — будут более крепкими. Существует несколько способов маринования грибов в домашних условиях, ниже мы приводим наиболее распространенные.
В эмалированную кастрюлю наливают 0,5 стакана воды, добавляют в нее 1,5 столовых ложки соли, 2/3 граненого стакана 8%-ного уксуса, доводят до кипения и опускают туда 1 кг заранее подготовленных грибов. Если маринад не покроет все грибы, опасаться не следует, поскольку при нагревании они выделят сок и окажутся полностью погруженными в маринад. Как только грибы закипят, нужно убавить огонь и варить их, осторожно помешивая. Пену необходимо снимать шумовкой. Пряности (2 лавровых листа, 2 шт. гвоздики, 5 горошин душистого перца, по 0,1 г корицы и бадьяна, на кончике ножа лимонной кислоты) добавляют после полного очищения маринада от пены. Тогда же следует добавить в маринад чайную ложку сахара.
Малоизвестные съедобные грибы: 1 — мокруха пурпуровая; 2 — коллибия лесолюбивая; 3 — лисичка серая; 4 — коллибия масляная; 5 — зонтик краснеющий; 6 — строфария сине-зеленая; 7 — лаковица розовая
На варочных пунктах, где заготавливают большое количество грибов, строго придерживаются определенной рецептуры.
В состав маринада, предназначенного для белых грибов, входят следующие компоненты (в граммах на 1 кг грибов): воды 120-140; соли ("Экстра" или помола № 0) 40-45; уксусной эссенции 80%-ной 6; лимонной кислоты 0,3; лаврового листа 0,2; перца душистого, гвоздики, корицы и бадьяна по 0,1. Состав маринада для рыжиков, валуев, подберезовиков, подосиновиков, маслят, лисичек и опенков сходен, однако в него не добавляют лимонную кислоту, гвоздику, корицу и бадьян, а уксуса добавляют вдвое меньше.
Варить грибы лучше всего в эмалированной посуде, причем для повышения качества их лучше опустить сразу в кипящую воду — будут более крепкими. Существует несколько способов маринования грибов в домашних условиях, ниже мы приводим наиболее распространенные.
В эмалированную кастрюлю наливают 0,5 стакана воды, добавляют в нее 1,5 столовых ложки соли, 2/3 граненого стакана 8%-ного уксуса, доводят до кипения и опускают туда 1 кг заранее подготовленных грибов. Если маринад не покроет все грибы, опасаться не следует, поскольку при нагревании они выделят сок и окажутся полностью погруженными в маринад. Как только грибы закипят, нужно убавить огонь и варить их, осторожно помешивая. Пену необходимо снимать шумовкой. Пряности (2 лавровых листа, 2 шт. гвоздики, 5 горошин душистого перца, по 0,1 г корицы и бадьяна, на кончике ножа лимонной кислоты) добавляют после полного очищения маринада от пены. Тогда же следует добавить в маринад чайную ложку сахара.
 Масленок лучше использовать для маринования
Шляпки белых грибов, подберезовиков, подосиновиков и маслят варят в кипящем маринаде 20-25, а ножки 15-20 мин; опенки, лисички, валуи и свинушки 25-30 мин. Грибы считаются готовыми, когда они опустятся на дно, а маринад станет прозрачным. После варки грибы охлаждают и раскладывают в плотно закрывающиеся банки. Маринованные грибы считаются готовыми к употреблению через месяц и могут долго храниться, будучи залитыми сверху растительным маслом или топленым бараньим жиром. Хранят их в эмалированной, деревянной, глиняной посуде или в плотно закрытых стеклянных банках, оптимальная для хранения температура 4-6oС. Известны и другие способы маринования грибов. Полезные советы в этом деле имеются в различных поваренных книгах, где можно подобрать способ маринования по собственному вкусу.
Масленок лучше использовать для маринования
Шляпки белых грибов, подберезовиков, подосиновиков и маслят варят в кипящем маринаде 20-25, а ножки 15-20 мин; опенки, лисички, валуи и свинушки 25-30 мин. Грибы считаются готовыми, когда они опустятся на дно, а маринад станет прозрачным. После варки грибы охлаждают и раскладывают в плотно закрывающиеся банки. Маринованные грибы считаются готовыми к употреблению через месяц и могут долго храниться, будучи залитыми сверху растительным маслом или топленым бараньим жиром. Хранят их в эмалированной, деревянной, глиняной посуде или в плотно закрытых стеклянных банках, оптимальная для хранения температура 4-6oС. Известны и другие способы маринования грибов. Полезные советы в этом деле имеются в различных поваренных книгах, где можно подобрать способ маринования по собственному вкусу.
 Чесночники чаще всего применяют в качестве пряной приправы к различным блюдам
В последние годы грибы довольно часто стали консервировать с применением стерилизации и герметического закупоривания. (Стерилизацией называется нагревание консервов до температуры свыше 100oС, во время которого в консервируемом продукте гибнут все микробы, вызывающие его порчу.) Однако практика показала, что в домашних условиях стерилизация грибов часто не удается, несмотря на то, что все требования этой операции вроде бы выполняются. Экспертиза случаев отравления грибными консервами показала, что даже при стерилизации в грибных консервах, представленных на экспертизу, какая-то часть микроорганизмов все же сохранилась, что вызвало разложение грибных белков и образование ядовитых веществ. Известно, что бактерии, разлагающие белок грибов, наиболее активны в пространствах без доступа воздуха, что и имело место в закупоренных банках с консервированными грибами. При доступе воздуха в соления или маринады токсические вещества не образуются, поэтому маринады и рассолы в этом отношении абсолютно безопасны. Вот почему консервация грибов в домашних условиях не рекомендуется.
Грибникам-любителям необходимо помнить, Что в соответствии с пунктом 7.10 "Санитарных правил по заготовке, переработке и продаже грибов" категорически запрещена продажа на рынках:
• грибов вареных, соленых, маринованных;
• икры, солянок, салатов и других продуктов из измельченных грибов;
• грибных "консервов" в банках с закатанными крышками, изготовленных в домашних условиях.
На рынках разрешается продажа только сушеных грибов: белых, подберезовиков, подосиновиков, моховиков, маслят, польского гриба, козляков, а также строчков и сморчков после 1-2-месячной выдержки в сушеном виде, т. е. практически у нас в средней полосе не раньше середины июня.
Большую роль в изучении грибов, а также в профилактике грибных отравлений играют выставки грибов, приуроченные обычно к основному грибному сезону. Такие выставки стали традиционными в Белоруссии, на Украине, в республиках Прибалтики. В Латвии, например, в залах Рижского музея природы ежегодно размещают живые экспонаты — более 100 видов грибов, произрастающих на территории республики. Экспозиция обычно воспроизводит в миниатюре заповедные уголки леса, лугов. Эта естественная среда, окружающая каждый гриб-экспонат, помогает посетителям лучше запомнить, как выглядит тот или иной гриб в природной обстановке, где его искать. Здесь же размещены и ядовитые грибы, снабженные этикетками с предупреждающими надписями. Эти броские надписи привлекают внимание посетителей: их нужно запомнить особенно хорошо — от этого зависит здоровье, а иногда и жизнь! В Киеве был выпущен и путеводитель по такой же выставке, снабженный черно-белыми рисунками, слайдами и описаниями представленных на ней грибов. В Москве в залах Биологического музея им К. А. Тимирязева уже дважды устраивались выставки грибов, но не живых, а искусно выполненных художником с натуры. Это очень полезный опыт. Познавательная роль таких выставок огромна и не может сравниться с плакатами, открытками, атласами грибов. Подобные выставки могут быть организованы и многими краеведческими музеями, имеющимися обычно в областных центрах.
Чесночники чаще всего применяют в качестве пряной приправы к различным блюдам
В последние годы грибы довольно часто стали консервировать с применением стерилизации и герметического закупоривания. (Стерилизацией называется нагревание консервов до температуры свыше 100oС, во время которого в консервируемом продукте гибнут все микробы, вызывающие его порчу.) Однако практика показала, что в домашних условиях стерилизация грибов часто не удается, несмотря на то, что все требования этой операции вроде бы выполняются. Экспертиза случаев отравления грибными консервами показала, что даже при стерилизации в грибных консервах, представленных на экспертизу, какая-то часть микроорганизмов все же сохранилась, что вызвало разложение грибных белков и образование ядовитых веществ. Известно, что бактерии, разлагающие белок грибов, наиболее активны в пространствах без доступа воздуха, что и имело место в закупоренных банках с консервированными грибами. При доступе воздуха в соления или маринады токсические вещества не образуются, поэтому маринады и рассолы в этом отношении абсолютно безопасны. Вот почему консервация грибов в домашних условиях не рекомендуется.
Грибникам-любителям необходимо помнить, Что в соответствии с пунктом 7.10 "Санитарных правил по заготовке, переработке и продаже грибов" категорически запрещена продажа на рынках:
• грибов вареных, соленых, маринованных;
• икры, солянок, салатов и других продуктов из измельченных грибов;
• грибных "консервов" в банках с закатанными крышками, изготовленных в домашних условиях.
На рынках разрешается продажа только сушеных грибов: белых, подберезовиков, подосиновиков, моховиков, маслят, польского гриба, козляков, а также строчков и сморчков после 1-2-месячной выдержки в сушеном виде, т. е. практически у нас в средней полосе не раньше середины июня.
Большую роль в изучении грибов, а также в профилактике грибных отравлений играют выставки грибов, приуроченные обычно к основному грибному сезону. Такие выставки стали традиционными в Белоруссии, на Украине, в республиках Прибалтики. В Латвии, например, в залах Рижского музея природы ежегодно размещают живые экспонаты — более 100 видов грибов, произрастающих на территории республики. Экспозиция обычно воспроизводит в миниатюре заповедные уголки леса, лугов. Эта естественная среда, окружающая каждый гриб-экспонат, помогает посетителям лучше запомнить, как выглядит тот или иной гриб в природной обстановке, где его искать. Здесь же размещены и ядовитые грибы, снабженные этикетками с предупреждающими надписями. Эти броские надписи привлекают внимание посетителей: их нужно запомнить особенно хорошо — от этого зависит здоровье, а иногда и жизнь! В Киеве был выпущен и путеводитель по такой же выставке, снабженный черно-белыми рисунками, слайдами и описаниями представленных на ней грибов. В Москве в залах Биологического музея им К. А. Тимирязева уже дважды устраивались выставки грибов, но не живых, а искусно выполненных художником с натуры. Это очень полезный опыт. Познавательная роль таких выставок огромна и не может сравниться с плакатами, открытками, атласами грибов. Подобные выставки могут быть организованы и многими краеведческими музеями, имеющимися обычно в областных центрах.
Грибы от весны до зимы
 Сморчковые грибы открывают грибной календарь в средней полосе
Определенные виды грибов довольно строго приурочены к определенному сезону года и месту обитания. Это обстоятельство дает возможность проследить очередность их появления от весны до зимы, что имеет значение не только с научной точки зрения, но и для работников потребительской кооперации, сельского хозяйства, лесной и пищевой промышленности.
Сезонность плодоношения разных грибов нашла отражение в народных приметах и пословицах:
• "Первый туман лета — верная грибная примета";
• "Появились опенки — лето кончилось";
• "Поздний грибок — поздний снежок" и др.
Даже само название некоторых грибов говорит об их приуроченности к определенным сезонам: летний опенок, вешенка осенняя, зимний гриб, строчок осенний и др.
Одна из причин далеко не полного и неудовлетворительного использования наших грибных богатств — отсутствие всеобъемлющего фенологического календаря, определяющего основные сроки плодоношения съедобных грибов в разных климатических зонах нашей страны с поправочными коэффициентами на погодные условия. Естественно, что составление такого календаря связано со значительным объемом исследований на громадных пространствах, что потребует привлечения к этой работе большого числа специалистов, однако необходимость создания его очевидна.
Сейчас уже составлены подробные сводки сроков плодоношения многих шляпочных грибов, в том числе съедобных, в Прибалтийских республиках, Белоруссии, на Украине, в Армении, Грузии и Приморье, а также в некоторых областях европейской части СССР. Тем не менее для огромных лесных пространств Сибири, Урала, севера европейской части, где заготовки грибов издавна были народным промыслом, до сих пор еще нет сколько-нибудь точных фенологических сводок.
Сморчковые грибы открывают грибной календарь в средней полосе
Определенные виды грибов довольно строго приурочены к определенному сезону года и месту обитания. Это обстоятельство дает возможность проследить очередность их появления от весны до зимы, что имеет значение не только с научной точки зрения, но и для работников потребительской кооперации, сельского хозяйства, лесной и пищевой промышленности.
Сезонность плодоношения разных грибов нашла отражение в народных приметах и пословицах:
• "Первый туман лета — верная грибная примета";
• "Появились опенки — лето кончилось";
• "Поздний грибок — поздний снежок" и др.
Даже само название некоторых грибов говорит об их приуроченности к определенным сезонам: летний опенок, вешенка осенняя, зимний гриб, строчок осенний и др.
Одна из причин далеко не полного и неудовлетворительного использования наших грибных богатств — отсутствие всеобъемлющего фенологического календаря, определяющего основные сроки плодоношения съедобных грибов в разных климатических зонах нашей страны с поправочными коэффициентами на погодные условия. Естественно, что составление такого календаря связано со значительным объемом исследований на громадных пространствах, что потребует привлечения к этой работе большого числа специалистов, однако необходимость создания его очевидна.
Сейчас уже составлены подробные сводки сроков плодоношения многих шляпочных грибов, в том числе съедобных, в Прибалтийских республиках, Белоруссии, на Украине, в Армении, Грузии и Приморье, а также в некоторых областях европейской части СССР. Тем не менее для огромных лесных пространств Сибири, Урала, севера европейской части, где заготовки грибов издавна были народным промыслом, до сих пор еще нет сколько-нибудь точных фенологических сводок.
Фенологический грибной календарь
Весна в средней полосе нашей страны не считается грибным сезоном, однако и в это время опытные грибники не возвращаются из леса с пустой корзиной. Открывается грибной календарь появлением таинственных, необычной формы, без трубочек и пластинок, прохладных на ощупь сумчатых грибов сморчков и строчков — первых весенних съедобных грибов, у которых даже трудно сразу определить, где образуются споры. Появляются эти грибы в середине апреля или, в зависимости от погоды, в начале мая, когда в средней полосе по оврагам, а местами и в лесу еще бывают нерастаявшие пласты снега (за раннее появление их прозвали грибами-подснежниками). Растут сморчки и строчки чаще на незадернованной почве, где побольше солнца, на лесных опушках, полянах, в мелколесье, у лесных дорог; сморчки часто можно встретить на местах старых костров и даже на обугленных пнях. В нашей стране растут два вида строчков: обыкновенный (наиболее распространенный) и большой. Строчок обыкновенный имеет волнистую мозговидную темно-бурую шляпку диаметром от 2 до 10 см, неправильной округлой формы и цилиндрическую бородавчатую или складчатую, нередко сплюснутую белую, желтоватую или красноватую ножку. Встречается этот гриб на песчаной почве в хвойных, особенно в сосновых, лесах, на вырубках и гарях довольно часто и обильно. При поисках строчков целесообразно также обратить особое внимание на обочины дорог, лесные тропинки, канавы. Часто строчки можно найти в местах складирования и окорки древесины. Строчок большой встречается довольно редко и растет на почве во влажных хвойных и лиственных лесах. У него довольно большая, от 6 до 30 см в диаметре, шляпка неправильной округлой или овальной формы, сильноскладчатая, светло-охряно-коричневая или светло-охряно-желтая. Ножка 3-6 см длиной и такой же толщины, белая или беловатая. В нашей стране эти грибы относят к условно съедобным, а в некоторых странах Европы — к ядовитым. При приготовлении блюд из этих грибов необходимо соблюдать все те условия, которые описаны в предыдущей главе; пренебрежение к выполнению всех предосторожностей недопустимо. Сморчки отличаются от строчков тем, что имеют шляпку с ячеистой поверхностью в отличие от складчатой или волнистой у строчков. Из 15 известных видов сморчков в нашей стране растут 5 видов, из них наиболее распространены сморчки обыкновенный, или настоящий, и конический.Наименование грибов | Месяцы | IV | V | VI | VII | VIII | IX | X
Сморчки | + | + | + | - | - | - | - Строчки | + | + | + | - | - | - | - Майский гриб | - | + | + | - | - | - | - Вешенка обыкновенная | - | + | + | + | + | + | + Луговой опенок | - | - | + | + | + | + | - Подберезовик | - | - | + | + | + | + | - Масленок зернистый | - | - | - | + | + | + | - Летний опенок | - | - | + | + | + | + | + Лисичка настоящая | - | - | - | + | + | + | - Белый гриб | - | - | + | + | + | + | + Подосиновик | - | - | + | + | + | + | + Плютей олений | - | - | + | + | + | + | + Дождевик шиповатый | - | + | + | + | + | + | + Шампиньон обыкновенный | - | - | + | + | + | + | - Шампиньон полевой | - | - | - | - | + | + | - Валуй | - | - | - | + | + | + | - Говорушка ворончатая | - | - | - | + | + | + | - Гриб-зонтик белый | - | - | - | + | + | + | - Гриб-зонтик пестрый | - | - | - | + | + | + | + Груздь настоящий | - | - | - | - | + | + | - Поддубовик | - | - | - | + | + | + | - Ивишень | - | - | - | - | + | + | + Подгруздок белый | - | - | - | - | + | + | - Подгруздок черный | - | - | - | - | + | + | - Свинушка толстая | - | - | - | - | + | + | - Сыроежка желтая, пищевая и др. | - | + | + | + | + | + | - Моховик зеленый | - | - | + | + | + | + | + Ежовик желтый | - | - | - | - | + | + | - Колпак кольчатый | - | - | - | + | + | + | - Масленок лиственничный | - | - | - | + | + | + | - Волнушка розовая | - | - | - | - | + | + | + Груздь черный | - | - | - | + | + | + | + Рыжик еловый зеленый | - | - | - | - | + | + | + Рыжик сосновый | - | - | - | - | + | + | + Говорушка серая | - | - | - | - | + | + | - Масленок поздний | - | - | - | - | + | + | - Зимний гриб | - | - | - | - | - | + | + Подгруздок черно-белый | - | - | - | - | - | + | + Польский гриб | - | - | - | - | + | - | - Вешенка осенняя | - | - | - | - | - | + | - Рядовка серая | - | - | - | - | - | + | - Строчок осенний | - | - | - | - | - | + | + Опенок осенний | - | - | - | - | - | + | + Рядовка фиолетовая | - | - | - | - | + | + | - Зеленушка | - | - | - | - | + | + | + Гигрофор бурый | - | - | - | - | - | + | +
 Сморчковая шапочка
Сморчок обыкновенный имеет яйцевидную или эллипсоидальную шляпку диаметром 6-15 см с поперечными и продольными ребрами, образующими ячейки неправильной формы, цвет ее охряно-бурый, бурый или серо-охряный. Ножка у гриба длиной 3-6 и толщиной 2-3 см, полая, у основания расширенная, беловатая или желтоватая. Встречается гриб в апреле — мае на почве в лиственных лесах и парках, преимущественно на освещенных местах.
У сморчка конического шляпка 2-8 см высотой и 1,5-4 см шириной, с правильно расположенными, сильно выступающими ребрами. Цвет ее бурый, желто-бурый, или серо-коричневый, причем ребра иногда бывают более темные. Ножка длиной 2-4,5 и толщиной 1,5-3 см, у основания суженная или слегка расширенная, тонкомучнистая, белая или желтоватая. Растет этот гриб на почве во влажных травянистых местах смешанных или хвойных лесов, на опушках и полянах, в парках и садах, одним словом там, где потеплее; часто его можно встретить на гарях, свалках, пустырях, по краям полей. При прохладной погоде сморчки и строчки не сходят до середины июня.
В некоторых странах сейчас изучается вопрос культивирования сморчка конического и уже получена культивированная грибница, что, безусловно, следует считать весьма обнадеживающим результатом, однако организовать выращивание этого гриба в промышленных масштабах еще не удалось.
В отличие от строчка обыкновенного сморчок конический вполне съедобен без предварительного отваривания. Именно эти грибы первыми можно увидеть весной на рынке.
На опушках лиственных лесов, особенно под осинами встречается сморчковая шапочка — гриб со светло-бурой, почти желтой шляпкой на длинной белой ножке. Чуть позже, в июне, к этим видам присоединяется лопастник ямчатый, довольно крупный гриб со шляпкой и ножкой серого цвета. Шляпка у него расчленена на отдельные лопасти, не срастающиеся с ножкой, и отличить этот гриб от строчка и сморчка довольно просто.
Сморчковая шапочка
Сморчок обыкновенный имеет яйцевидную или эллипсоидальную шляпку диаметром 6-15 см с поперечными и продольными ребрами, образующими ячейки неправильной формы, цвет ее охряно-бурый, бурый или серо-охряный. Ножка у гриба длиной 3-6 и толщиной 2-3 см, полая, у основания расширенная, беловатая или желтоватая. Встречается гриб в апреле — мае на почве в лиственных лесах и парках, преимущественно на освещенных местах.
У сморчка конического шляпка 2-8 см высотой и 1,5-4 см шириной, с правильно расположенными, сильно выступающими ребрами. Цвет ее бурый, желто-бурый, или серо-коричневый, причем ребра иногда бывают более темные. Ножка длиной 2-4,5 и толщиной 1,5-3 см, у основания суженная или слегка расширенная, тонкомучнистая, белая или желтоватая. Растет этот гриб на почве во влажных травянистых местах смешанных или хвойных лесов, на опушках и полянах, в парках и садах, одним словом там, где потеплее; часто его можно встретить на гарях, свалках, пустырях, по краям полей. При прохладной погоде сморчки и строчки не сходят до середины июня.
В некоторых странах сейчас изучается вопрос культивирования сморчка конического и уже получена культивированная грибница, что, безусловно, следует считать весьма обнадеживающим результатом, однако организовать выращивание этого гриба в промышленных масштабах еще не удалось.
В отличие от строчка обыкновенного сморчок конический вполне съедобен без предварительного отваривания. Именно эти грибы первыми можно увидеть весной на рынке.
На опушках лиственных лесов, особенно под осинами встречается сморчковая шапочка — гриб со светло-бурой, почти желтой шляпкой на длинной белой ножке. Чуть позже, в июне, к этим видам присоединяется лопастник ямчатый, довольно крупный гриб со шляпкой и ножкой серого цвета. Шляпка у него расчленена на отдельные лопасти, не срастающиеся с ножкой, и отличить этот гриб от строчка и сморчка довольно просто.
 Майский гриб, или калоцибе майский, встречается в европейской части СССР в лесах, на лугах, пастбищах и даже на газонах парков и скверов
В мае появляется и плодоносит до июля один из самых ранних шляпочных пластинчатых грибов калоцибе майский, рядовка майская, майский гриб, или майка. Весь гриб белый или слегка кремовый с плотной выпуклой шляпкой. У старых грибов шляпка может приобретать охряный оттенок разной интенсивности. Приросшие к ножке пластинки и мякоть гриба тоже белые. Гриб имеет вкус и запах свежей муки. Употребляется свежим.
С наступлением лета количество грибов постепенно увеличивается. В июне появляются некоторые шляпочные грибы, растущие на полуразложившейся древесине, которая прогревается быстрее, чем почва. Самым массовым съедобным грибом июня можно считать летний опенок, который поселяется большими семьями на пнях, бревнах, гнилушках лиственных пород. Летний опенок имеет довольно крупную шляпку, диаметром от 2 до 6 см. У молодого гриба шляпка полукруглая, но с возрастом она становится плоско-выпуклой, а при полном созревании почти распростертой, с опущенным вниз краем. В центре шляпки — широкоокруглый выступающий бугорок, окраска шляпки ржаво-буро-коричневая с концентрическими водянистыми более светлыми просвечивающимися полосками. Мякоть у летнего опенка тонкая, белая, водянистая. Ножка у гриба высотой 3,5-5 и толщиной 0,3-0,4 см, цилиндрическая, книзу немного суженная, полая, выше кольца кремовая, ниже бурая. Кольцо одного цвета со шляпкой, иногда оно исчезает, но на ножке от него остается четкий след. Летний опенок широко распространен, у нас его можно встретить практически везде, где есть лес. Разработан также способ его культивирования на древесине и опилках. Употребляют этот гриб в свежем виде для приготовления жаркого или для тушения. Тонкие шляпки для длительного хранения лучше всего сушить. Период плодоношения этих грибов при хорошей погоде может продлиться до конца сентября. Кроме летнего опенка, в июне появляются и другие съедобные грибы, многие из которых грибники, к сожалению, мало знают и поэтому не берут.
Майский гриб, или калоцибе майский, встречается в европейской части СССР в лесах, на лугах, пастбищах и даже на газонах парков и скверов
В мае появляется и плодоносит до июля один из самых ранних шляпочных пластинчатых грибов калоцибе майский, рядовка майская, майский гриб, или майка. Весь гриб белый или слегка кремовый с плотной выпуклой шляпкой. У старых грибов шляпка может приобретать охряный оттенок разной интенсивности. Приросшие к ножке пластинки и мякоть гриба тоже белые. Гриб имеет вкус и запах свежей муки. Употребляется свежим.
С наступлением лета количество грибов постепенно увеличивается. В июне появляются некоторые шляпочные грибы, растущие на полуразложившейся древесине, которая прогревается быстрее, чем почва. Самым массовым съедобным грибом июня можно считать летний опенок, который поселяется большими семьями на пнях, бревнах, гнилушках лиственных пород. Летний опенок имеет довольно крупную шляпку, диаметром от 2 до 6 см. У молодого гриба шляпка полукруглая, но с возрастом она становится плоско-выпуклой, а при полном созревании почти распростертой, с опущенным вниз краем. В центре шляпки — широкоокруглый выступающий бугорок, окраска шляпки ржаво-буро-коричневая с концентрическими водянистыми более светлыми просвечивающимися полосками. Мякоть у летнего опенка тонкая, белая, водянистая. Ножка у гриба высотой 3,5-5 и толщиной 0,3-0,4 см, цилиндрическая, книзу немного суженная, полая, выше кольца кремовая, ниже бурая. Кольцо одного цвета со шляпкой, иногда оно исчезает, но на ножке от него остается четкий след. Летний опенок широко распространен, у нас его можно встретить практически везде, где есть лес. Разработан также способ его культивирования на древесине и опилках. Употребляют этот гриб в свежем виде для приготовления жаркого или для тушения. Тонкие шляпки для длительного хранения лучше всего сушить. Период плодоношения этих грибов при хорошей погоде может продлиться до конца сентября. Кроме летнего опенка, в июне появляются и другие съедобные грибы, многие из которых грибники, к сожалению, мало знают и поэтому не берут.
 Летний опенок
Ориентироваться в огромном грибном царстве непросто, ведь грибов насчитывается около 100 тыс. видов, из которых около 10 тыс. крупных (макромицетов). Примерно 300 видов макромицетов съедобны , почти все они встречаются на территории нашей страны, однако собирают не более 60, причем и эти виды знают далеко не все грибники.
В июне и июле на гниющей древесине лиственных и хвойных пород, особенно сосны, можно увидеть по два — три хрупких гриба на высоких тонких белых ножках с серовато-коричневыми шляпками и широкими нежно-розовыми пластинками. Это плютей олений, очень нежный съедобный гриб с сочной мякотью. Не исключено, что плютей — лакомство для многих копытных, в том числе и оленей, откуда, вероятно, и произошло его название. Но грибники, как правило, плютей не берут, а в некоторых странах его вообще относят к несъедобным грибам.
В это же время в средней полосе на стволах различных лиственных деревьев, особенно на дубе, появляются трутовики серно-желтые, которые в молодом возрасте вполне съедобны. Грибы эти растут большими группами, причем из каждой такой группы (общая масса грибов до 5 кг!) можно приготовить жаркое на семью.
Поскольку серно-желтый трутовик, появляясь на живых деревьях, вызывает бурую сердцевинную гниль, собирая его, мы одновременно уничтожаем опасного паразита.
На пнях и реже на валеже лиственных пород деревьев большими группами появляется в июне вешенка обыкновенная с белой или сероватой шляпкой. Этот гриб не сходит до конца июля, а иногда встречается даже в августе. Вешенку обыкновенную можно встретить на всей территории нашей страны: гриб имеет очень приятный вкус и запах. В последнее время его стали культивировать.
В первый летний месяц можно иногда найти и подосиновик, подберезовик, а в конце месяца и белый гриб. Растут эти грибы чаще под березами в неглубоких овражках, ложбинах и канавках, где задерживаются опавшие осенние листья, хвоя и мелкий хворост. По краям огородов, на выгонах, в садах и парках, на унавоженной земле в это же время появляются, причем очень обильно, шампиньоны обыкновенный, или печерица, и тротуарный, или двукольцевой. Эти грибы как бы тянутся к человеческому жилью. В Москве, например, их собирают на бульварах в черте города.
Летний опенок
Ориентироваться в огромном грибном царстве непросто, ведь грибов насчитывается около 100 тыс. видов, из которых около 10 тыс. крупных (макромицетов). Примерно 300 видов макромицетов съедобны , почти все они встречаются на территории нашей страны, однако собирают не более 60, причем и эти виды знают далеко не все грибники.
В июне и июле на гниющей древесине лиственных и хвойных пород, особенно сосны, можно увидеть по два — три хрупких гриба на высоких тонких белых ножках с серовато-коричневыми шляпками и широкими нежно-розовыми пластинками. Это плютей олений, очень нежный съедобный гриб с сочной мякотью. Не исключено, что плютей — лакомство для многих копытных, в том числе и оленей, откуда, вероятно, и произошло его название. Но грибники, как правило, плютей не берут, а в некоторых странах его вообще относят к несъедобным грибам.
В это же время в средней полосе на стволах различных лиственных деревьев, особенно на дубе, появляются трутовики серно-желтые, которые в молодом возрасте вполне съедобны. Грибы эти растут большими группами, причем из каждой такой группы (общая масса грибов до 5 кг!) можно приготовить жаркое на семью.
Поскольку серно-желтый трутовик, появляясь на живых деревьях, вызывает бурую сердцевинную гниль, собирая его, мы одновременно уничтожаем опасного паразита.
На пнях и реже на валеже лиственных пород деревьев большими группами появляется в июне вешенка обыкновенная с белой или сероватой шляпкой. Этот гриб не сходит до конца июля, а иногда встречается даже в августе. Вешенку обыкновенную можно встретить на всей территории нашей страны: гриб имеет очень приятный вкус и запах. В последнее время его стали культивировать.
В первый летний месяц можно иногда найти и подосиновик, подберезовик, а в конце месяца и белый гриб. Растут эти грибы чаще под березами в неглубоких овражках, ложбинах и канавках, где задерживаются опавшие осенние листья, хвоя и мелкий хворост. По краям огородов, на выгонах, в садах и парках, на унавоженной земле в это же время появляются, причем очень обильно, шампиньоны обыкновенный, или печерица, и тротуарный, или двукольцевой. Эти грибы как бы тянутся к человеческому жилью. В Москве, например, их собирают на бульварах в черте города.
 Шампиньон тротуарный
Шампиньон обыкновенный довольно крупный гриб, шляпка его бывает от 8 до 15 см в диаметре. Сначала она полушарювидная с глубоко загнутым внутрь краем, затем плоско-округлая и, наконец, распростертая, часто с выпуклым центром, сухая, шелковистая или мелкочешуйчатая. Окраска ее бывает белая, иногда буроватая, мякоть белая, на изломе краснеющая, а пластинки сначала белые, потом розовые, а при созревании темно-коричневые с фиолетовым оттенком. Ножка высотой 5-9 и толщиной 1-2 см, прямая или в основании расширенная и вздутая, одного цвета со шляпкой, с широким белым кольцом, чаще расположенным ближе к середине. Шампиньон тротуарный растет в лиственных лесах, парках, на огородах, часто встречается на улицах городов в трещинах асфальта. Шляпка у него 3-15 см в диаметре, очень толстая (до 2,5 см толщиной), полуокруглая, грязновато-белая. Мякоть белая и на изломе розовеет. Ножка толстая, высотой 4-7 и толщиной 2-4 см, с двумя кольцами. Одновременно с этими грибами на лугах, опушках лесов, полянах появляется их собрат — шампиньон полевой.
Шампиньон тротуарный
Шампиньон обыкновенный довольно крупный гриб, шляпка его бывает от 8 до 15 см в диаметре. Сначала она полушарювидная с глубоко загнутым внутрь краем, затем плоско-округлая и, наконец, распростертая, часто с выпуклым центром, сухая, шелковистая или мелкочешуйчатая. Окраска ее бывает белая, иногда буроватая, мякоть белая, на изломе краснеющая, а пластинки сначала белые, потом розовые, а при созревании темно-коричневые с фиолетовым оттенком. Ножка высотой 5-9 и толщиной 1-2 см, прямая или в основании расширенная и вздутая, одного цвета со шляпкой, с широким белым кольцом, чаще расположенным ближе к середине. Шампиньон тротуарный растет в лиственных лесах, парках, на огородах, часто встречается на улицах городов в трещинах асфальта. Шляпка у него 3-15 см в диаметре, очень толстая (до 2,5 см толщиной), полуокруглая, грязновато-белая. Мякоть белая и на изломе розовеет. Ножка толстая, высотой 4-7 и толщиной 2-4 см, с двумя кольцами. Одновременно с этими грибами на лугах, опушках лесов, полянах появляется их собрат — шампиньон полевой.
 Говорушка ворончатая
Июль — разгар лета, в лесу уже поспела земляника и черника, пахнет разогретая солнцем сосновая смола и особенно остро ощущается терпкий аромат хвои. К этому времени увеличивается и количество грибов. На почве в хвойных и лиственных лесах с богатым слоем опада в обилии появляется говорушка ворончатая — тонкомясистый гриб с желтоватой или белой воронковидной шляпкой и низбегающими на ножку пластинками. У молодого гриба шляпка несколько выпуклая, но потом она разрастается в глубокую воронку. Говорушка ворончатая — съедобный и приятный на вкус гриб, но с тонкой и жесткой мякотью. При сборе следует остерегаться мелких белых, с тонкой мякотью говорушек, особенно имеющих частые нисходящие пластинки, так как среди них встречаются ядовитые.
Говорушка ворончатая
Июль — разгар лета, в лесу уже поспела земляника и черника, пахнет разогретая солнцем сосновая смола и особенно остро ощущается терпкий аромат хвои. К этому времени увеличивается и количество грибов. На почве в хвойных и лиственных лесах с богатым слоем опада в обилии появляется говорушка ворончатая — тонкомясистый гриб с желтоватой или белой воронковидной шляпкой и низбегающими на ножку пластинками. У молодого гриба шляпка несколько выпуклая, но потом она разрастается в глубокую воронку. Говорушка ворончатая — съедобный и приятный на вкус гриб, но с тонкой и жесткой мякотью. При сборе следует остерегаться мелких белых, с тонкой мякотью говорушек, особенно имеющих частые нисходящие пластинки, так как среди них встречаются ядовитые.
 Поддубовик
На лесных полянах, на опушках, вырубках и лугах можно найти малоизвестные грибникам, но вполне съедобные грибы-зонтики, шляпка которых достигает в диаметре 25 см (у зонтика пестрого). Шляпку несколько меньших размеров имеет реже встречающийся гриб-зонтик белый. Оба гриба обладают нежной мякотью и высоко ценятся грибниками в странах Центральной и Западной Европы, причем зонтик пестрый можно есть даже сырым, употребляя его нарезанным ломтиками, для бутербродов.
Поддубовик
На лесных полянах, на опушках, вырубках и лугах можно найти малоизвестные грибникам, но вполне съедобные грибы-зонтики, шляпка которых достигает в диаметре 25 см (у зонтика пестрого). Шляпку несколько меньших размеров имеет реже встречающийся гриб-зонтик белый. Оба гриба обладают нежной мякотью и высоко ценятся грибниками в странах Центральной и Западной Европы, причем зонтик пестрый можно есть даже сырым, употребляя его нарезанным ломтиками, для бутербродов.
 Гриб-зонтик пестрый
В июле в широколиственных лесах появляется и дубовик, или поддубовик, типичный для этих лесов гриб, внешне очень похожий на белый, но имеющий желтую, быстро синеющую на изломе мякоть, за что на Украине и в Белоруссии его называют синяк. Можно найти в это время и гриб ивишень, или подвишень, белый крупный съедобный. С июля по сентябрь можно собирать его, не уходя далеко от дома, так как из лиственных лесов он заходит в сады, где часто поселяется под вишнями — здесь и влажность большая и теплее, чем под яблонями. От других грибов ивишень отличается желтовато-розовыми пластинками, низко спускающимися на ножку. В естественных условиях он встречается в светлых лесах — на опушках и полянах, часто среди мхов, особенно обильно растет на Украине и в Белоруссии.
Гриб-зонтик пестрый
В июле в широколиственных лесах появляется и дубовик, или поддубовик, типичный для этих лесов гриб, внешне очень похожий на белый, но имеющий желтую, быстро синеющую на изломе мякоть, за что на Украине и в Белоруссии его называют синяк. Можно найти в это время и гриб ивишень, или подвишень, белый крупный съедобный. С июля по сентябрь можно собирать его, не уходя далеко от дома, так как из лиственных лесов он заходит в сады, где часто поселяется под вишнями — здесь и влажность большая и теплее, чем под яблонями. От других грибов ивишень отличается желтовато-розовыми пластинками, низко спускающимися на ножку. В естественных условиях он встречается в светлых лесах — на опушках и полянах, часто среди мхов, особенно обильно растет на Украине и в Белоруссии.
 Поплавок
В смешанных и лиственных лесах в середине лета появляется один из грибов-баранов — трутовик листоватый, или грифола курчавая, а в лиственничных лесах и в посадках лиственницы — яркий лиственничный масленок с золотисто-желтой шляпкой и такой же мякотью. Плодовое тело гриба-барана состоит из центральной дважды ветвящейся ножки и многочисленных плоских мелких шляпок. Общая масса плодового тела в свежем состоянии до 10 кг, а диаметр до 40 см. Развивается этот гриб как паразит на корнях дуба, реже граба и бука в зоне широколиственных лесов и в горных лесах Европы, Северной Америки и Австралии, в нашей стране встречается на Кавказе, Украине, в Прибалтике и Приморье. Это вполне съедобный гриб, однако встречается он очень редко. В конце сентября 1980 г. в Москве под одним из дубов, окружающих территорию Останкинской телевизионной башни, был найден гриб-баран массой 6,5 кг.
Поплавок
В смешанных и лиственных лесах в середине лета появляется один из грибов-баранов — трутовик листоватый, или грифола курчавая, а в лиственничных лесах и в посадках лиственницы — яркий лиственничный масленок с золотисто-желтой шляпкой и такой же мякотью. Плодовое тело гриба-барана состоит из центральной дважды ветвящейся ножки и многочисленных плоских мелких шляпок. Общая масса плодового тела в свежем состоянии до 10 кг, а диаметр до 40 см. Развивается этот гриб как паразит на корнях дуба, реже граба и бука в зоне широколиственных лесов и в горных лесах Европы, Северной Америки и Австралии, в нашей стране встречается на Кавказе, Украине, в Прибалтике и Приморье. Это вполне съедобный гриб, однако встречается он очень редко. В конце сентября 1980 г. в Москве под одним из дубов, окружающих территорию Останкинской телевизионной башни, был найден гриб-баран массой 6,5 кг.
 Синяк, или гиропорус синеющий
Масленок лиственничный — съедобный гриб с очень приятным вкусом и запахом. Он довольно крупный, диаметр шляпки до 14 см, кожица со шляпки легко снимается. Встречается этот гриб почти на всей территории нашей страны, где имеется лиственница. Масленок лиственничный — симбионт, его грибница плотно оплетает корни лиственницы, и такое сосуществование полезно и дереву и грибу. Используют гриб в жареном или тушеном виде. Слизистую оболочку шляпки следует удалить вместе с мусором. При сушке нежная мякоть масленка настолько ссыхается, что ее потом практически невозможно размочить, поэтому сушить его не рекомендуется.
Синяк, или гиропорус синеющий
Масленок лиственничный — съедобный гриб с очень приятным вкусом и запахом. Он довольно крупный, диаметр шляпки до 14 см, кожица со шляпки легко снимается. Встречается этот гриб почти на всей территории нашей страны, где имеется лиственница. Масленок лиственничный — симбионт, его грибница плотно оплетает корни лиственницы, и такое сосуществование полезно и дереву и грибу. Используют гриб в жареном или тушеном виде. Слизистую оболочку шляпки следует удалить вместе с мусором. При сушке нежная мякоть масленка настолько ссыхается, что ее потом практически невозможно размочить, поэтому сушить его не рекомендуется.
 Сыроежка
Теплый июль открывает и яркий хоровод разноцветных сыроежек, их появляется около 10 видов: золотисто-желтая, лиловая, бордовая, вильчатая с разветвленными пластинками, буровато-зеленой шляпкой и несдирающейся кожицей и др. Это одновременно и холодостойкие и теплолюбивые грибы, поэтому их можно встретить в лесах разного типа, правда, отдельные виды приурочены к хвойным или лиственным лесам, например сыроежка золотисто-желтая, растущая преимущественно в широколиственных лесах.
Среди обширного рода сыроежек особую пищевую ценность представляют сыроежки пищевая, синевато-зеленая, желтая и буреющая.
Сыроежка пищевая - средний по размеру гриб с красно-фиолетовой бурого оттенка шляпкой диаметром от 4 до 10 см. Растет она в сырых смешанных лесах, часто по обочинам дорог и тропинок. Употребляется в жареных и тушеных блюдах, обладает своеобразным ореховым вкусом. Хранить ее можно в сушеном виде.
Сыроежка синевато-зеленая в действительности имеет зеленовато-серую шляпку диаметром от 5 до 14 см. Для нее характерны бурые пятна на пластинках; у молодых грибов пластинки белые, у взрослых желтоватые. Вкус гриба мягкий, молодые сыроежки слегка горчат, однако при обработке грибов горечь исчезает. Сыроежку синевато-зеленую употребляют в жареных и тушеных блюдах; для хранения ее можно сушить.
Сыроежка желтая имеет ярко-желтую шляпку, растет в сырых березняках. Это деликатесный первоклассный гриб, который можно использовать в самых различных блюдах. В силу недостаточного знакомства с грибами, мы оставляема сожалению, в лесу многие из сыроежек, в том числе и желтую, в то время как во многих европейских странах они являются самыми желанными для грибников.
Сыроежка буреющая тоже относится к деликатесным грибам. Шляпка ее диаметром до 12 см бывает темно-красной, оливково-бурой или желто-буроватой с зеленоватым отливом. У гриба приятный, пикантный вкус, чем-то напоминающий селедку, поэтому при приготовлении из нее блюд не рекомендуется добавлять грибы другого вида. Хранить эту сыроежку лучше в замороженном виде, так как при сушке мякоть ее настолько ссыхается и твердеет, что потом ее приходится очень долго размачивать. Сыроежки пурпурно-красноватая и сереющая тоже относятся к хорошим съедобным грибам.
В самых разных по породному составу лесах на полянах в июле можно встретить тоже малоизвестный грибникам ближайший родственник мухомора, но вполне съедобный гриб поплавок, основание ножки которого помещено как бы в бокальчик. Поплавок, или толкачик (так его называют в Белоруссии) — очень интересный гриб, главным образом потому, что его шляпка бывает самой разнообразной окраски: белая, серая, желто-коричневая, розово-желтая, оранжевая. По этой причине микологи до сих пор еще не решили, один ли это вид с различной окраской или это различные виды поплавков.
Из ядовитых грибов в середине лета появляется мухомор пантерный. Чтобы не испортить грибное блюдо, в это время следует также опасаться двух горьких на вкус несъедобных грибов: перечного и желчного, растущих в сухих, главным образом сосновых лесах.
В последней декаде июля в лесах разного типа, но с примесью березы появляются валуи, а в светлых мелколиственных — свинушки толстая и тонкая, а также летний, или зернистый, масленок.
Валуй — крупный гриб с плотной мякотью, имеющей жгучий горький вкус и неприятный запах сырости. Во многих районах нашей страны, в частности в Белоруссии, его считают съедобным грибом, вполне годным для соления. Однако в Скандинавских странах, где он очень обилен, его к съедобным грибам не причисляют, хотя и ядовитым не считают. На опушках молодых лесов в конце июля можно найти гриб чесночник с желтоватой шляпкой. Он имеет сильный чесночный запах и поэтому охотно используется любителями для приготовления различных приправ. В нашей стране растут и употребляются в пищу в основном три вида чесночников: мелкий, дубовый и большой. Чесночник мелкий поселяется в сухих местах на лесной подстилке, глинистой и песчаной почве и на пнях в различных типах леса в основном по опушкам. Этот гриб можно встретить и в сентябре. Распространен он в европейской части, на Кавказе, в Сибири и Приморье. Шляпка у него 1-3 см в диаметре, желто-бурая или слегка охристая, по мере созревания становится палевой.
Чесночник дубовый надо искать в дубовых и смешанных лесах на опавших дубовых листьях. Распространен он только в европейской части нашей страны и появляется осенью — в сентябре и октябре. Шляпка у него 2-3 см в диаметре, сначала колокольчатая, затем округло-выпуклая, полуперепончатая, морщинистая, грязно-палевая, реже беловатая. В сырую погоду на шляпке образуется полосатый край; ножка тонкая, высотой 5-8 и диаметром 0,2-0,4 см.
У чесночника большого шляпка до 5 см в диаметре, буровато-беловатая, иногда в молодом возрасте молочно-белая, позжетемнеющая. Мякоть шляпки белая, а ножки темная. Растут эти грибы группами в лиственных, чаще в буковых и реже в хвойных лесах на пнях и валеже с июля по ноябрь. Распространены в европейской части, на Кавказе и в Сибири.
Чесночники относятся к роду негниючников, так как они засыхают, но не загнивают. Кроме чесночников, к этому роду принадлежит еще один съедобный гриб — луговой опенок, появляющийся на лугах в июле. Плодовые тела гриба часто образуют ведьмины кольца. Шляпка у лугового опенка диаметром 2-6 см, желтовато-бурая. Гриб съедобный, с хорошими вкусовыми качествами. Собирают только его шляпки — они ароматны, хороши и в супе, и жареные, и тушеные. Хорошо эти грибы сушить (легко высыхают) и потом использовать для приготовления супов и соусов.
Сыроежка
Теплый июль открывает и яркий хоровод разноцветных сыроежек, их появляется около 10 видов: золотисто-желтая, лиловая, бордовая, вильчатая с разветвленными пластинками, буровато-зеленой шляпкой и несдирающейся кожицей и др. Это одновременно и холодостойкие и теплолюбивые грибы, поэтому их можно встретить в лесах разного типа, правда, отдельные виды приурочены к хвойным или лиственным лесам, например сыроежка золотисто-желтая, растущая преимущественно в широколиственных лесах.
Среди обширного рода сыроежек особую пищевую ценность представляют сыроежки пищевая, синевато-зеленая, желтая и буреющая.
Сыроежка пищевая - средний по размеру гриб с красно-фиолетовой бурого оттенка шляпкой диаметром от 4 до 10 см. Растет она в сырых смешанных лесах, часто по обочинам дорог и тропинок. Употребляется в жареных и тушеных блюдах, обладает своеобразным ореховым вкусом. Хранить ее можно в сушеном виде.
Сыроежка синевато-зеленая в действительности имеет зеленовато-серую шляпку диаметром от 5 до 14 см. Для нее характерны бурые пятна на пластинках; у молодых грибов пластинки белые, у взрослых желтоватые. Вкус гриба мягкий, молодые сыроежки слегка горчат, однако при обработке грибов горечь исчезает. Сыроежку синевато-зеленую употребляют в жареных и тушеных блюдах; для хранения ее можно сушить.
Сыроежка желтая имеет ярко-желтую шляпку, растет в сырых березняках. Это деликатесный первоклассный гриб, который можно использовать в самых различных блюдах. В силу недостаточного знакомства с грибами, мы оставляема сожалению, в лесу многие из сыроежек, в том числе и желтую, в то время как во многих европейских странах они являются самыми желанными для грибников.
Сыроежка буреющая тоже относится к деликатесным грибам. Шляпка ее диаметром до 12 см бывает темно-красной, оливково-бурой или желто-буроватой с зеленоватым отливом. У гриба приятный, пикантный вкус, чем-то напоминающий селедку, поэтому при приготовлении из нее блюд не рекомендуется добавлять грибы другого вида. Хранить эту сыроежку лучше в замороженном виде, так как при сушке мякоть ее настолько ссыхается и твердеет, что потом ее приходится очень долго размачивать. Сыроежки пурпурно-красноватая и сереющая тоже относятся к хорошим съедобным грибам.
В самых разных по породному составу лесах на полянах в июле можно встретить тоже малоизвестный грибникам ближайший родственник мухомора, но вполне съедобный гриб поплавок, основание ножки которого помещено как бы в бокальчик. Поплавок, или толкачик (так его называют в Белоруссии) — очень интересный гриб, главным образом потому, что его шляпка бывает самой разнообразной окраски: белая, серая, желто-коричневая, розово-желтая, оранжевая. По этой причине микологи до сих пор еще не решили, один ли это вид с различной окраской или это различные виды поплавков.
Из ядовитых грибов в середине лета появляется мухомор пантерный. Чтобы не испортить грибное блюдо, в это время следует также опасаться двух горьких на вкус несъедобных грибов: перечного и желчного, растущих в сухих, главным образом сосновых лесах.
В последней декаде июля в лесах разного типа, но с примесью березы появляются валуи, а в светлых мелколиственных — свинушки толстая и тонкая, а также летний, или зернистый, масленок.
Валуй — крупный гриб с плотной мякотью, имеющей жгучий горький вкус и неприятный запах сырости. Во многих районах нашей страны, в частности в Белоруссии, его считают съедобным грибом, вполне годным для соления. Однако в Скандинавских странах, где он очень обилен, его к съедобным грибам не причисляют, хотя и ядовитым не считают. На опушках молодых лесов в конце июля можно найти гриб чесночник с желтоватой шляпкой. Он имеет сильный чесночный запах и поэтому охотно используется любителями для приготовления различных приправ. В нашей стране растут и употребляются в пищу в основном три вида чесночников: мелкий, дубовый и большой. Чесночник мелкий поселяется в сухих местах на лесной подстилке, глинистой и песчаной почве и на пнях в различных типах леса в основном по опушкам. Этот гриб можно встретить и в сентябре. Распространен он в европейской части, на Кавказе, в Сибири и Приморье. Шляпка у него 1-3 см в диаметре, желто-бурая или слегка охристая, по мере созревания становится палевой.
Чесночник дубовый надо искать в дубовых и смешанных лесах на опавших дубовых листьях. Распространен он только в европейской части нашей страны и появляется осенью — в сентябре и октябре. Шляпка у него 2-3 см в диаметре, сначала колокольчатая, затем округло-выпуклая, полуперепончатая, морщинистая, грязно-палевая, реже беловатая. В сырую погоду на шляпке образуется полосатый край; ножка тонкая, высотой 5-8 и диаметром 0,2-0,4 см.
У чесночника большого шляпка до 5 см в диаметре, буровато-беловатая, иногда в молодом возрасте молочно-белая, позжетемнеющая. Мякоть шляпки белая, а ножки темная. Растут эти грибы группами в лиственных, чаще в буковых и реже в хвойных лесах на пнях и валеже с июля по ноябрь. Распространены в европейской части, на Кавказе и в Сибири.
Чесночники относятся к роду негниючников, так как они засыхают, но не загнивают. Кроме чесночников, к этому роду принадлежит еще один съедобный гриб — луговой опенок, появляющийся на лугах в июле. Плодовые тела гриба часто образуют ведьмины кольца. Шляпка у лугового опенка диаметром 2-6 см, желтовато-бурая. Гриб съедобный, с хорошими вкусовыми качествами. Собирают только его шляпки — они ароматны, хороши и в супе, и жареные, и тушеные. Хорошо эти грибы сушить (легко высыхают) и потом использовать для приготовления супов и соусов.
 Луговые опята никогда не загнивают, а засыхают 'на корню'; эта их особенность нашла свое отражение в русском названии рода грибов, к которому они относятся, — негниючник
В смешанных лесах в июле появляются два подгруздка — белый, или сухарь, сухой груздь, и черный, или чернушка, который, правда, предпочитает сосновый лес. Оба эти вида отличаются от настоящих груздей тем, что не имеют млечного сока.
Луговые опята никогда не загнивают, а засыхают 'на корню'; эта их особенность нашла свое отражение в русском названии рода грибов, к которому они относятся, — негниючник
В смешанных лесах в июле появляются два подгруздка — белый, или сухарь, сухой груздь, и черный, или чернушка, который, правда, предпочитает сосновый лес. Оба эти вида отличаются от настоящих груздей тем, что не имеют млечного сока.
 Подгруздок белый
Подгруздок белый - довольно крупный гриб, размер его шляпки от 5 до 20 см. Сначала шляпка выпуклая, но по мере созревания становится воронковидной. Мякоть гриба белая со сладковатым, слегка острым вкусом. У подгруздка белого весьма обширный ареал: Европа, включая европейскую часть СССР, Кавказ, Алтайский край, Дальний Восток.
Подгруздок белый
Подгруздок белый - довольно крупный гриб, размер его шляпки от 5 до 20 см. Сначала шляпка выпуклая, но по мере созревания становится воронковидной. Мякоть гриба белая со сладковатым, слегка острым вкусом. У подгруздка белого весьма обширный ареал: Европа, включая европейскую часть СССР, Кавказ, Алтайский край, Дальний Восток.
 Подгруздок черный
Плодовое тело подгруздка белого начинает формироваться под землей, и по мере роста гриб поднимает на своей шляпке остатки грунта и лесной подстилки, выполняя роль рыхлителя грунта. Из-за этой особенности найти молодой подгруздок довольно трудно, а старый, который хорошо виден, почти всегда оказывается червивым. Этот гриб съедобен, особенно в жареном виде, тушить его не рекомендуется, но можно солить в смеси с другими грибами.
Подгруздок черный
Плодовое тело подгруздка белого начинает формироваться под землей, и по мере роста гриб поднимает на своей шляпке остатки грунта и лесной подстилки, выполняя роль рыхлителя грунта. Из-за этой особенности найти молодой подгруздок довольно трудно, а старый, который хорошо виден, почти всегда оказывается червивым. Этот гриб съедобен, особенно в жареном виде, тушить его не рекомендуется, но можно солить в смеси с другими грибами.
 Лисички
У подгруздка черного шляпка от 5 до 15 см в диаметре, находили грибы и со шляпкой до 25 см. Сначала шляпка выпуклая, затем выпукло-распростертая, в центре вдавленная, в молодом возрасте светлая, позже палевая или серовато-коричневая, а у зрелого гриба от грязно-буроватой до темно-бурой. На ощупь кожица шляпки слегка клейкая и не снимается. Встречается подгруздок черный с июля по октябрь почти во всех странах Европы, у нас в европейской части и в Сибири преимущественно в сосновых лесах. Этот гриб съедобен после предварительного отваривания, но с довольно низкими вкусовыми качествами, поскольку имеет своеобразный запах, отдающий сырой землей. Его можно использовать для засола, желательно в смеси с другими грибами.
Лисички
У подгруздка черного шляпка от 5 до 15 см в диаметре, находили грибы и со шляпкой до 25 см. Сначала шляпка выпуклая, затем выпукло-распростертая, в центре вдавленная, в молодом возрасте светлая, позже палевая или серовато-коричневая, а у зрелого гриба от грязно-буроватой до темно-бурой. На ощупь кожица шляпки слегка клейкая и не снимается. Встречается подгруздок черный с июля по октябрь почти во всех странах Европы, у нас в европейской части и в Сибири преимущественно в сосновых лесах. Этот гриб съедобен после предварительного отваривания, но с довольно низкими вкусовыми качествами, поскольку имеет своеобразный запах, отдающий сырой землей. Его можно использовать для засола, желательно в смеси с другими грибами.
 Подберезовик
В июле все чаще начинают попадаться подберезовики и подосиновики, иногда и одиночные белые грибы. Но все же июль относительно небогат грибами, основное их изобилие впереди.
Подберезовик
В июле все чаще начинают попадаться подберезовики и подосиновики, иногда и одиночные белые грибы. Но все же июль относительно небогат грибами, основное их изобилие впереди.
 Моховик
Наступление, продолжительность и окончание плодоношения определяются, с одной стороны, биологическими свойствами грибов, а с другой — условиями погоды текущего года и отчасти предшествующего года или нескольких предшествующих лет. От биологических свойств зависит наступление плодоношения грибов, причем в условиях определенной местности в более или менее определенные сроки. Условия погоды влияют на то, что сроки плодоношения колеблются вокруг этого среднего времени, обусловленного биологическими свойствами. Таким образом, комбинацией этих двух зависимостей в конечном счете определяются сроки появления плодовых тел в те или иные годы и в течение 1 года, а также величина урожая. Однако зависимость между сроками плодоношения, условиями погоды и биологическими свойствами разных видов грибов проявляется не всегда достаточно четко, и если иногда она оказывается вполне очевидной и ее учитывают даже местные жители, то в некоторых случаях, наоборот, она бывает не ясна даже для современной науки. Поскольку богатые урожаи грибов и полные неурожаи наблюдаются у нас в стране довольно редко, мы будем рассматривать средний случай.
Моховик
Наступление, продолжительность и окончание плодоношения определяются, с одной стороны, биологическими свойствами грибов, а с другой — условиями погоды текущего года и отчасти предшествующего года или нескольких предшествующих лет. От биологических свойств зависит наступление плодоношения грибов, причем в условиях определенной местности в более или менее определенные сроки. Условия погоды влияют на то, что сроки плодоношения колеблются вокруг этого среднего времени, обусловленного биологическими свойствами. Таким образом, комбинацией этих двух зависимостей в конечном счете определяются сроки появления плодовых тел в те или иные годы и в течение 1 года, а также величина урожая. Однако зависимость между сроками плодоношения, условиями погоды и биологическими свойствами разных видов грибов проявляется не всегда достаточно четко, и если иногда она оказывается вполне очевидной и ее учитывают даже местные жители, то в некоторых случаях, наоборот, она бывает не ясна даже для современной науки. Поскольку богатые урожаи грибов и полные неурожаи наблюдаются у нас в стране довольно редко, мы будем рассматривать средний случай.
 Подосиновик
Известно, что грибы плодоносят волнами, или слоями, когда в короткий срок вдруг появляется много плодовых тел. У нас в средней полосе обычно бывает три или четыре таких грибных слоя. Первый, сравнительно слабый, появляется здесь во второй половине июля и только при очень благоприятных сочетаниях температуры и влажности. Второй и третий, самые обильные, слои приходятся на август, сентябрь и частично октябрь. Как и почему это происходит, точного ответа на этот вопрос мы дать еще не можем.
Подосиновик
Известно, что грибы плодоносят волнами, или слоями, когда в короткий срок вдруг появляется много плодовых тел. У нас в средней полосе обычно бывает три или четыре таких грибных слоя. Первый, сравнительно слабый, появляется здесь во второй половине июля и только при очень благоприятных сочетаниях температуры и влажности. Второй и третий, самые обильные, слои приходятся на август, сентябрь и частично октябрь. Как и почему это происходит, точного ответа на этот вопрос мы дать еще не можем.
 Мало кому известная лаковица
Итак, в средней полосе основной грибной сезон начинается в августе — с каждым днем общее число видов шляпочных грибов возрастает. Пополняется семья сыроежек: появляются ломкая, красная, фиолетовая, сереющая в сосновых сыроватых лесах, сине-желтая в сосново-березовых лесах и др. На сосновых пнях и около них можно найти крупный съедобный гриб рядовку желто-красную со шляпкой от 5 до 10 см в диаметре. Кожица на шляпке желто-оранжевая с многочисленными мелкими красноватыми волокнистыми чешуйками, отчего она кажется красноватой. Растут рядовки группами, встречаются до октября.
В сосновых и смешанных лесах появляется в августе и рядовка серая — малоизвестный съедобный гриб, получивший название, по-видимому, за характер роста рядами или кольцами, где каждый гриб стоит одиночно, но все вместе образуют линию, как говорят, стоят рядком. Это хорошие съедобные грибы с приятным запахом муки, но, как все грибы с плотной мякотью, требуют основательной термообработки; хранить их можно в сушеном виде. Рядовку серую не следует путать с несъедобной рядовкой заостренной, имеющей жгуче-горький вкус, способный испортить любое грибное блюдо.
Мало кому известная лаковица
Итак, в средней полосе основной грибной сезон начинается в августе — с каждым днем общее число видов шляпочных грибов возрастает. Пополняется семья сыроежек: появляются ломкая, красная, фиолетовая, сереющая в сосновых сыроватых лесах, сине-желтая в сосново-березовых лесах и др. На сосновых пнях и около них можно найти крупный съедобный гриб рядовку желто-красную со шляпкой от 5 до 10 см в диаметре. Кожица на шляпке желто-оранжевая с многочисленными мелкими красноватыми волокнистыми чешуйками, отчего она кажется красноватой. Растут рядовки группами, встречаются до октября.
В сосновых и смешанных лесах появляется в августе и рядовка серая — малоизвестный съедобный гриб, получивший название, по-видимому, за характер роста рядами или кольцами, где каждый гриб стоит одиночно, но все вместе образуют линию, как говорят, стоят рядком. Это хорошие съедобные грибы с приятным запахом муки, но, как все грибы с плотной мякотью, требуют основательной термообработки; хранить их можно в сушеном виде. Рядовку серую не следует путать с несъедобной рядовкой заостренной, имеющей жгуче-горький вкус, способный испортить любое грибное блюдо.
 Нельзя смешивать съедобную рядовку серую с очень похожей на нее ядовитой рядовкой заостренной с бугорком на шляпке
В августе на стволах лиственных деревьев, особенно на березе и осине, созревает чешуйчатка золотистая, или ивняк, с коричневыми пластинками. Этот гриб растет большими группами и находка его — удача для грибника.
В широколиственных и смешанных лесах вырастают в это же время первые млечники, например молочай, или гладыш, с красновато-бурой шляпкой. В странах Западной Европы он считается очень ценным съедобным грибом, а у нас его редко собирают, хотя в засоле он, пожалуй, немногим уступит королю млечников — ароматному рыжику. Нужно отметить, что в Поволжье русское название гладыш относится к другому грибу — млечнику мясо-красному со шляпкой багрово-красного цвета, растущему в еловых и смешанных лесах с августа по сентябрь.
В изреженных лесах, на лесных полянах, вырубках обильной бывает лаковица розовая — тоже малоизвестный, но вполне съедобный гриб. Встретить его можно с июля по октябрь почти по всей территории СССР. Шляпка его до 5 см в диаметре, розовато-буро-охристая, но позже выцветает, становясь белесоватой. В августе появляются зеленый и пестрый моховики и польский гриб из этого же рода.
Моховик зеленый растет в самых разных лесах, предпочитая лесные поляны, опушки края дорог, иногда и муравейники. Ареал его охватывает почти все страны Европы, европейскую часть СССР, Кавказ, Урал, Сибирь, Дальний Восток, Северную Америку, Австралию, о. Калимантан. Гриб этот имеет очень приятный вкус и фруктовый запах, годен преимущественно для сушки и маринования, однако хорош также сваренный и жареный, правда, ценность его снижается из-за ватно-рыхлой мякоти. Моховик пестрый, или трещиноватый, тоже довольно широко распространен — растет в лиственных и смешанных лесах Европы, Сибири, Кавказа, Дальнего Востока, Северной Америки, Австралии. Шляпка у него 3-10 см в диаметре, выпуклая, сухая, матовая, коричневого, красновато-коричневого, оливково-коричневого или охряно-серого цвета, сетчато растрескивающаяся, причем эти трещины часто имеют розовый оттенок. Употребляется он так же, как моховик зеленый.
Нельзя смешивать съедобную рядовку серую с очень похожей на нее ядовитой рядовкой заостренной с бугорком на шляпке
В августе на стволах лиственных деревьев, особенно на березе и осине, созревает чешуйчатка золотистая, или ивняк, с коричневыми пластинками. Этот гриб растет большими группами и находка его — удача для грибника.
В широколиственных и смешанных лесах вырастают в это же время первые млечники, например молочай, или гладыш, с красновато-бурой шляпкой. В странах Западной Европы он считается очень ценным съедобным грибом, а у нас его редко собирают, хотя в засоле он, пожалуй, немногим уступит королю млечников — ароматному рыжику. Нужно отметить, что в Поволжье русское название гладыш относится к другому грибу — млечнику мясо-красному со шляпкой багрово-красного цвета, растущему в еловых и смешанных лесах с августа по сентябрь.
В изреженных лесах, на лесных полянах, вырубках обильной бывает лаковица розовая — тоже малоизвестный, но вполне съедобный гриб. Встретить его можно с июля по октябрь почти по всей территории СССР. Шляпка его до 5 см в диаметре, розовато-буро-охристая, но позже выцветает, становясь белесоватой. В августе появляются зеленый и пестрый моховики и польский гриб из этого же рода.
Моховик зеленый растет в самых разных лесах, предпочитая лесные поляны, опушки края дорог, иногда и муравейники. Ареал его охватывает почти все страны Европы, европейскую часть СССР, Кавказ, Урал, Сибирь, Дальний Восток, Северную Америку, Австралию, о. Калимантан. Гриб этот имеет очень приятный вкус и фруктовый запах, годен преимущественно для сушки и маринования, однако хорош также сваренный и жареный, правда, ценность его снижается из-за ватно-рыхлой мякоти. Моховик пестрый, или трещиноватый, тоже довольно широко распространен — растет в лиственных и смешанных лесах Европы, Сибири, Кавказа, Дальнего Востока, Северной Америки, Австралии. Шляпка у него 3-10 см в диаметре, выпуклая, сухая, матовая, коричневого, красновато-коричневого, оливково-коричневого или охряно-серого цвета, сетчато растрескивающаяся, причем эти трещины часто имеют розовый оттенок. Употребляется он так же, как моховик зеленый.
 Рядовка желто-красная
У польского гриба, который легко можно спутать с белым грибом, шляпка до 15 см в диаметре, выпуклая, у молодых экземпляров с матовой замшевой поверхностью; мякоть беловатая или желтоватая, на разрезе сначала синеющая, затем буреющая. Гриб имеет очень приятный вкус и годится в жаркое, для сушки, маринования, варки. Растет преимущественно в сосновых лесах европейской части СССР, Западной Европы, Северной Америки, Австралии и Монголии.
Из ядовитых грибов в августе еще встречается мухомор пантерный с бурой или серовато-оливковой шляпкой, покрытой белыми концентрически расположенными хлопьями.
Начиная с ранней весны и до конца октября, а иногда и в ноябре на лесном опаде, остатках травянистых растений, мертвой древесине и подстилке появляется много видов коллибий, мицен и негниючников. У нас в стране насчитывается около 60 видов рода мицен, 20 — рода коллибий, около 35 — рода негниючников и 30 видов рода навозников. За небольшим исключением все они несъедобны, однако играют очень важную роль в почвообразовании, разлагая лесной опад и мертвую древесину. В северных районах нашей страны ведущая-роль в разрушении органических веществ принадлежит грибам, определенные виды которых способны выполнять эту работу даже под снежным покровом.
В соответствии с грибным календарем в первой половине августа, когда в средней полосе начинается основной грибной сезон, появляются любимейшие наши грибы — рыжики и грузди, основные промысловые виды. Интересно отметить, что в старину к сбору рыжиков предъявлялись особые требования: для рынка собирались только молодые, мелкие, со шляпкой не более 2,5 см в диаметре.
Рядовка желто-красная
У польского гриба, который легко можно спутать с белым грибом, шляпка до 15 см в диаметре, выпуклая, у молодых экземпляров с матовой замшевой поверхностью; мякоть беловатая или желтоватая, на разрезе сначала синеющая, затем буреющая. Гриб имеет очень приятный вкус и годится в жаркое, для сушки, маринования, варки. Растет преимущественно в сосновых лесах европейской части СССР, Западной Европы, Северной Америки, Австралии и Монголии.
Из ядовитых грибов в августе еще встречается мухомор пантерный с бурой или серовато-оливковой шляпкой, покрытой белыми концентрически расположенными хлопьями.
Начиная с ранней весны и до конца октября, а иногда и в ноябре на лесном опаде, остатках травянистых растений, мертвой древесине и подстилке появляется много видов коллибий, мицен и негниючников. У нас в стране насчитывается около 60 видов рода мицен, 20 — рода коллибий, около 35 — рода негниючников и 30 видов рода навозников. За небольшим исключением все они несъедобны, однако играют очень важную роль в почвообразовании, разлагая лесной опад и мертвую древесину. В северных районах нашей страны ведущая-роль в разрушении органических веществ принадлежит грибам, определенные виды которых способны выполнять эту работу даже под снежным покровом.
В соответствии с грибным календарем в первой половине августа, когда в средней полосе начинается основной грибной сезон, появляются любимейшие наши грибы — рыжики и грузди, основные промысловые виды. Интересно отметить, что в старину к сбору рыжиков предъявлялись особые требования: для рынка собирались только молодые, мелкие, со шляпкой не более 2,5 см в диаметре.
 Рыжик еловый
Грибы всегда занимали значительное место в рационе русских людей, а когда наступал пост (обычно это бывало перед отелом, когда коровы уже не давали молока и когда по весне истощались запасы зерна и мяса), грибы, в основном соленые рыжики и грузди, а также сушеные белые, занимали вместе с некоторыми овощами основное место на столе. Вот почему летом, когда выдавались свободные часы от неотложных полевых работ, все отправлялись в лес по грибы, памятуя о том, что это будет большое подспорье зимой.
Рыжик еловый
Грибы всегда занимали значительное место в рационе русских людей, а когда наступал пост (обычно это бывало перед отелом, когда коровы уже не давали молока и когда по весне истощались запасы зерна и мяса), грибы, в основном соленые рыжики и грузди, а также сушеные белые, занимали вместе с некоторыми овощами основное место на столе. Вот почему летом, когда выдавались свободные часы от неотложных полевых работ, все отправлялись в лес по грибы, памятуя о том, что это будет большое подспорье зимой.
 Рыжик сосновый
Рыжики относятся к группе млечников. Название млечники дано за то, что все грибы этой группы содержат в мякоти очень едкий на вкус млечный сок, обычно теряющий едкость при кулинарной обработке. Достаточно разломить такой гриб, чтобы по обильно выступающему, чаще всего белому соку установить, что имеешь дело с млечником. У некоторых грибов на воздухе сок быстро меняет окраску на зеленую или красную.
Рыжиков у нас имеется несколько форм и даже видов. Наиболее известным и распространенным является настоящий, или деликатесный, рыжик, у которого есть две формы: рыжик сосновый с оранжевой или даже красно-оранжевой шляпкой и рыжик еловый, окрашенный более скромно, в желтоватые или синевато-зеленоватые тона. У этих форм хорошо выражены на шляпке более темные концентрические зоны, а оранжевый млечный сок, появляющийся на изломе, быстро зеленеет; шляпка и ножка при прикосновении к ним тоже быстро покрываются зелеными пятнами. Очень характерен запах млечного сока — острый смолисто-фруктовый, за который этот гриб очень ценится и который сохраняется при холодном способе засола. Употребляют рыжики не только солеными, но и свежими, зажаренными в сметане или на вертеле (по старинному русскому способу, практиковавшемуся охотниками).-В старину грибоводы-любители выращивали рыжик, сажая его грибницу в парках под 5-6-летними елями или соснами.
Мнение о рыжике как о типичном представителе русской флоры неверно. Эти грибы имеют широкий ареал (страны Западной Европы, Северная Америка, страны Азии, Скандинавские страны), причем съедобными их считают даже в тех странах, где все остальные млечники относят к ядовитым. Рыжики окрашивают мочу в красный цвет, но это совершенно безопасно для здоровья.
Другой знаменитый гриб-млечник — груздь. У нас растет несколько видов груздей: настоящий, или сырой, желтый, черный, осиновый, дубовый, перечный. Растут эти грибы обычно большими группами (грудами), мостясь друг на друге, еще говорят, что растут они гнездами или стаями. Грузди издавна славились на Руси как первоклассные грибы для засола. Когда-то их вместе с рыжиками даже выделяли из других грибов, говоря о них "родится много грибов, рыжиков, груздей" или "брать грибы и ломать грузди".
Рыжик сосновый
Рыжики относятся к группе млечников. Название млечники дано за то, что все грибы этой группы содержат в мякоти очень едкий на вкус млечный сок, обычно теряющий едкость при кулинарной обработке. Достаточно разломить такой гриб, чтобы по обильно выступающему, чаще всего белому соку установить, что имеешь дело с млечником. У некоторых грибов на воздухе сок быстро меняет окраску на зеленую или красную.
Рыжиков у нас имеется несколько форм и даже видов. Наиболее известным и распространенным является настоящий, или деликатесный, рыжик, у которого есть две формы: рыжик сосновый с оранжевой или даже красно-оранжевой шляпкой и рыжик еловый, окрашенный более скромно, в желтоватые или синевато-зеленоватые тона. У этих форм хорошо выражены на шляпке более темные концентрические зоны, а оранжевый млечный сок, появляющийся на изломе, быстро зеленеет; шляпка и ножка при прикосновении к ним тоже быстро покрываются зелеными пятнами. Очень характерен запах млечного сока — острый смолисто-фруктовый, за который этот гриб очень ценится и который сохраняется при холодном способе засола. Употребляют рыжики не только солеными, но и свежими, зажаренными в сметане или на вертеле (по старинному русскому способу, практиковавшемуся охотниками).-В старину грибоводы-любители выращивали рыжик, сажая его грибницу в парках под 5-6-летними елями или соснами.
Мнение о рыжике как о типичном представителе русской флоры неверно. Эти грибы имеют широкий ареал (страны Западной Европы, Северная Америка, страны Азии, Скандинавские страны), причем съедобными их считают даже в тех странах, где все остальные млечники относят к ядовитым. Рыжики окрашивают мочу в красный цвет, но это совершенно безопасно для здоровья.
Другой знаменитый гриб-млечник — груздь. У нас растет несколько видов груздей: настоящий, или сырой, желтый, черный, осиновый, дубовый, перечный. Растут эти грибы обычно большими группами (грудами), мостясь друг на друге, еще говорят, что растут они гнездами или стаями. Грузди издавна славились на Руси как первоклассные грибы для засола. Когда-то их вместе с рыжиками даже выделяли из других грибов, говоря о них "родится много грибов, рыжиков, груздей" или "брать грибы и ломать грузди".
 Груздь настоящий
Появлению груздей способствуют частые, но не обильные дожди. При перенасыщении почвы влагой появившиеся было грибы исчезают. "Зарядили дожди — груздей не жди",- говорит одна из пословиц.
Груздь настоящий
Появлению груздей способствуют частые, но не обильные дожди. При перенасыщении почвы влагой появившиеся было грибы исчезают. "Зарядили дожди — груздей не жди",- говорит одна из пословиц.
 Груздь желтый
Первое место по кулинарным и вкусовым качествам, особенно по аромату, занимает груздь настоящий, или сырой, с белой или кремово-желтой шляпкой, по которой слабозаметны водянистые зоны; края шляпки как бы подвернуты и густо опущены. Млечный сок у груздя настоящего белый, но на воздухе становится серно-желтым. Растет настоящий груздь в березовых или сосново-березовых лесах, причем ареал его охватывает не только европейскую часть, но и Сибирь, а также многие страны Западной Европы, где этот гриб также имеет хозяйственное значение. На груздь настоящий очень похож груздь желтый. Этот гриб растет чаще в еловых и елово-пихтовых лесах, реже встречается в березняках. У него довольно крупная шляпка, от 5 до 15 см в диаметре, а встречается он в европейской части и на Дальнем Востоке. В пищу употребляется соленым.
Груздь желтый
Первое место по кулинарным и вкусовым качествам, особенно по аромату, занимает груздь настоящий, или сырой, с белой или кремово-желтой шляпкой, по которой слабозаметны водянистые зоны; края шляпки как бы подвернуты и густо опущены. Млечный сок у груздя настоящего белый, но на воздухе становится серно-желтым. Растет настоящий груздь в березовых или сосново-березовых лесах, причем ареал его охватывает не только европейскую часть, но и Сибирь, а также многие страны Западной Европы, где этот гриб также имеет хозяйственное значение. На груздь настоящий очень похож груздь желтый. Этот гриб растет чаще в еловых и елово-пихтовых лесах, реже встречается в березняках. У него довольно крупная шляпка, от 5 до 15 см в диаметре, а встречается он в европейской части и на Дальнем Востоке. В пищу употребляется соленым.
 Груздь черный
Появляющийся в августе груздь черный выделяется среди своих сородичей большими размерами. Шляпка его достигает 20 см в диаметре, с желтым краем, очень плотная, мясистая, бывает зеленовато-бурой или темно-бурой, почти черной, при засоле становится винно-красной. Млечный сок белый, очень обильный и едкий. Растет этот гриб преимущественно в березовых и смешанных лесах. В ряде областей нашей страны его называют чернушкой, так же, как и подгруздок черный, который относится не к млечникам, а к роду сыроежек и млечного сока не имеет. Груздь черный используют для засола после предварительного отваривания. Интересно отметить, что груздь черный можно искать даже после первых заморозков, если за ними последует продолжительный период с положительными температурами, как это бывает в средней полосе в конце октября — начале ноября.
В это же время года в сыроватых осиновых лесах довольно редко, но местами довольно обильно появляется груздь осиновый, у которого беловатая шляпка с буроватыми или красноватыми пятнами и красивыми кремовато-розоватого цвета пластинками.
Груздь черный
Появляющийся в августе груздь черный выделяется среди своих сородичей большими размерами. Шляпка его достигает 20 см в диаметре, с желтым краем, очень плотная, мясистая, бывает зеленовато-бурой или темно-бурой, почти черной, при засоле становится винно-красной. Млечный сок белый, очень обильный и едкий. Растет этот гриб преимущественно в березовых и смешанных лесах. В ряде областей нашей страны его называют чернушкой, так же, как и подгруздок черный, который относится не к млечникам, а к роду сыроежек и млечного сока не имеет. Груздь черный используют для засола после предварительного отваривания. Интересно отметить, что груздь черный можно искать даже после первых заморозков, если за ними последует продолжительный период с положительными температурами, как это бывает в средней полосе в конце октября — начале ноября.
В это же время года в сыроватых осиновых лесах довольно редко, но местами довольно обильно появляется груздь осиновый, у которого беловатая шляпка с буроватыми или красноватыми пятнами и красивыми кремовато-розоватого цвета пластинками.
 Скрипица
Значительно реже можно найти груздь дубовый, растущий в широколиственных лесах. У него желтая или желто-оранжевая шляпка и короткая толстая с желтоватыми пятнами ножка. Едкий млечный белый сок этого гриба не изменяет на воздухе своей окраски. Все грузди обычно плодоносят и в сентябре.
Скрипица
Значительно реже можно найти груздь дубовый, растущий в широколиственных лесах. У него желтая или желто-оранжевая шляпка и короткая толстая с желтоватыми пятнами ножка. Едкий млечный белый сок этого гриба не изменяет на воздухе своей окраски. Все грузди обычно плодоносят и в сентябре.
 Волнушка
В августе в березовых лесах появляется в изобилии волнушка розовая — хороший съедобный гриб, требующий, однако, предварительного отваривания. Волнушка розовая — один из самых популярных съедобных грибов в Скандинавских странах, где очень многие грибники считают ее вообще чуть ли не единственным съедобным грибом. У молодых грибов шляпка розовая с красными концентрическими кольцами. Из соленых, рубленных с луком волнушек можно приготовить приятный острый салат или грибную подливу, грибы можно также жарить и хранить в замороженном виде.
В августовских лиственных и хвойных лесах обильно плодоносят млечники, особенно скрипица — белый гриб с очень горьким едким белым млечным соком, не меняющим окраски на воздухе. Мякоть у скрипицы очень плотная, жесткая, желтеюшая на изломе. Растут эти грибы обычно большими группами с июля по сентябрь почти по всей территории нашей страны. В пищу употребляются только солеными, причем обрабатываются грибы горячим способом после предварительного тщательного вымачивания. Скрипица обладает низкими вкусовыми качествами и во многих странах считается несъедобным грибом.
Горячим способом обрабатывается перед употреблением в пищу и горькушка. В средней полосе большинство грибов-млечников сходит в сентябре, до октября задерживаются только рыжики, горькушка и черный груздь.
Многие грибы-млечники имеют полую ножку, как бы с дуплом, в силу чего некоторые из них называют дуплянками. Млечник обыкновенный, или желтая дуплянка, с серовато-желтой шляпкой растет во влажных местах хвойных и смешанных лесов среди мхов с августа по сентябрь. В некоторых районах называют этот гриб гладышем, как и молочай. Белый млечный сок желтой дуплянки на воздухе становится желтым или зеленовато-желтым. Этот гриб пригоден для засолки.
Нужно отметить, что строение ножки у многих млечников определяет и способ их сбора. Поскольку выкрутить эти грибы из почвы, не сломав полую хрупкую ножку, невозможно, их целесообразно срезать.
Среди млечников ядовитые виды неизвестны, но съедобность некоторых из них, таких, как млечник серо-розовый, млечник шиповатый и некоторые другие, сомнительна или точно не установлена. Поэтому всегда следует собирать только хорошо знакомые грибы.
Всего род млечников насчитывает около 90 видов, из которых на территории нашей страны произрастает около 50. Большинство из них находится в тесной связи с корнями деревьев, а потому и растет преимущественно в лесах.
Выше были описаны наиболее распространенные млечники, которые являются объектами массового сбора и заготовок. Но грибы-млечники могут доставить и другое удовольствие. Вспомните, слова С. Т. Аксакова о том, как приятно "бережно вынимать из-под пелены прошлогодних и полусгнивших листьев, поросших всякими лесными травами и цветами... остро пахнущие, хрупкие и ломкие, точно пухом обросшие снизу молодые грузди". Часто сбор грибов превращается в занятие, приносящее огромное эстетическое наслаждение и несравнимый ни с чем душевный покой...
Кроме многочисленных млечников, во второй половине августа появляется много других съедобных грибов, которые грибники зачастую совершенно несправедливо обходят стороной. Так, в еловых лесах, появляется мокруха еловая с желтоватой слизистой шляпкой и слизистой пленкой-покрывалом, прикрывающей молодые пластинки. Растет мокруха поодиночке в ельниках или других лесах с примесью ели. Это хороший съедобный гриб, несмотря на то, что очень ломкая мякоть затрудняет его использование. Определенную неприятность при сборе доставляет слизистая поверхность гриба и то, что он может испачкать и корзину и остальные грибы, поэтому класть его следует отдельно от других грибов, правда, пятна от мокрухи смываются довольно легко. Мокруха вкусна в жареных и тушеных блюдах.
Волнушка
В августе в березовых лесах появляется в изобилии волнушка розовая — хороший съедобный гриб, требующий, однако, предварительного отваривания. Волнушка розовая — один из самых популярных съедобных грибов в Скандинавских странах, где очень многие грибники считают ее вообще чуть ли не единственным съедобным грибом. У молодых грибов шляпка розовая с красными концентрическими кольцами. Из соленых, рубленных с луком волнушек можно приготовить приятный острый салат или грибную подливу, грибы можно также жарить и хранить в замороженном виде.
В августовских лиственных и хвойных лесах обильно плодоносят млечники, особенно скрипица — белый гриб с очень горьким едким белым млечным соком, не меняющим окраски на воздухе. Мякоть у скрипицы очень плотная, жесткая, желтеюшая на изломе. Растут эти грибы обычно большими группами с июля по сентябрь почти по всей территории нашей страны. В пищу употребляются только солеными, причем обрабатываются грибы горячим способом после предварительного тщательного вымачивания. Скрипица обладает низкими вкусовыми качествами и во многих странах считается несъедобным грибом.
Горячим способом обрабатывается перед употреблением в пищу и горькушка. В средней полосе большинство грибов-млечников сходит в сентябре, до октября задерживаются только рыжики, горькушка и черный груздь.
Многие грибы-млечники имеют полую ножку, как бы с дуплом, в силу чего некоторые из них называют дуплянками. Млечник обыкновенный, или желтая дуплянка, с серовато-желтой шляпкой растет во влажных местах хвойных и смешанных лесов среди мхов с августа по сентябрь. В некоторых районах называют этот гриб гладышем, как и молочай. Белый млечный сок желтой дуплянки на воздухе становится желтым или зеленовато-желтым. Этот гриб пригоден для засолки.
Нужно отметить, что строение ножки у многих млечников определяет и способ их сбора. Поскольку выкрутить эти грибы из почвы, не сломав полую хрупкую ножку, невозможно, их целесообразно срезать.
Среди млечников ядовитые виды неизвестны, но съедобность некоторых из них, таких, как млечник серо-розовый, млечник шиповатый и некоторые другие, сомнительна или точно не установлена. Поэтому всегда следует собирать только хорошо знакомые грибы.
Всего род млечников насчитывает около 90 видов, из которых на территории нашей страны произрастает около 50. Большинство из них находится в тесной связи с корнями деревьев, а потому и растет преимущественно в лесах.
Выше были описаны наиболее распространенные млечники, которые являются объектами массового сбора и заготовок. Но грибы-млечники могут доставить и другое удовольствие. Вспомните, слова С. Т. Аксакова о том, как приятно "бережно вынимать из-под пелены прошлогодних и полусгнивших листьев, поросших всякими лесными травами и цветами... остро пахнущие, хрупкие и ломкие, точно пухом обросшие снизу молодые грузди". Часто сбор грибов превращается в занятие, приносящее огромное эстетическое наслаждение и несравнимый ни с чем душевный покой...
Кроме многочисленных млечников, во второй половине августа появляется много других съедобных грибов, которые грибники зачастую совершенно несправедливо обходят стороной. Так, в еловых лесах, появляется мокруха еловая с желтоватой слизистой шляпкой и слизистой пленкой-покрывалом, прикрывающей молодые пластинки. Растет мокруха поодиночке в ельниках или других лесах с примесью ели. Это хороший съедобный гриб, несмотря на то, что очень ломкая мякоть затрудняет его использование. Определенную неприятность при сборе доставляет слизистая поверхность гриба и то, что он может испачкать и корзину и остальные грибы, поэтому класть его следует отдельно от других грибов, правда, пятна от мокрухи смываются довольно легко. Мокруха вкусна в жареных и тушеных блюдах.
 Дуплянка серая(серушка) имеет полую ножку, откуда и ее название. Млечный сок этого гриба на воздухе не меняет, как сок многих других млечников. Растет серушка в березовых и осиновых лесах с июля по сентябрь
Во влажных сосновых и смешанных лесах, по закраинам лесных болот селится крупный съедобный гриб колпак кольчатый с мясистой желто-розовой шляпкой. Во второй половине августа в массовом количестве появляются и лисички — очень вкусные грибы, растущие группами, и ежовик желтый. В молодых сосняках обилен в конце августа и масленок поздний — съедобный гриб, предпочитающий лесные опушки и обочины дорог; в этих же местах можно найти и шампиньон полевой с желтеющей от прикосновения белой шляпкой.
В конце лета на опушках хвойных и смешанных лесов можно найти и такой типично осенний гриб, как говорушку серую, которая часто образует так называемые "ведьмины кольца". Плодоносит она и в октябре, а найти ее в это время можно не только в светлых лесах, но и в садах.
И еще один малоизвестный съедобный гриб появляется в конце августа в смешанных лесах — строфария сине-зеленая с редкой для грибов, синевато-зеленоватой окраской шляпки и ножки. Этот гриб можно встретить на пнях, особенно хвойных пород, на пастбищах, свалках.
Конец лета — время появления многочисленных ядовитых грибов — мухоморов красного, вонючего, порфирового, поганковидного и смертельно ядовитой бледной поганки.
Дуплянка серая(серушка) имеет полую ножку, откуда и ее название. Млечный сок этого гриба на воздухе не меняет, как сок многих других млечников. Растет серушка в березовых и осиновых лесах с июля по сентябрь
Во влажных сосновых и смешанных лесах, по закраинам лесных болот селится крупный съедобный гриб колпак кольчатый с мясистой желто-розовой шляпкой. Во второй половине августа в массовом количестве появляются и лисички — очень вкусные грибы, растущие группами, и ежовик желтый. В молодых сосняках обилен в конце августа и масленок поздний — съедобный гриб, предпочитающий лесные опушки и обочины дорог; в этих же местах можно найти и шампиньон полевой с желтеющей от прикосновения белой шляпкой.
В конце лета на опушках хвойных и смешанных лесов можно найти и такой типично осенний гриб, как говорушку серую, которая часто образует так называемые "ведьмины кольца". Плодоносит она и в октябре, а найти ее в это время можно не только в светлых лесах, но и в садах.
И еще один малоизвестный съедобный гриб появляется в конце августа в смешанных лесах — строфария сине-зеленая с редкой для грибов, синевато-зеленоватой окраской шляпки и ножки. Этот гриб можно встретить на пнях, особенно хвойных пород, на пастбищах, свалках.
Конец лета — время появления многочисленных ядовитых грибов — мухоморов красного, вонючего, порфирового, поганковидного и смертельно ядовитой бледной поганки.
 Колпак кольчатый
Август — самый щедрый, самый обильный плодами месяц лета: поспевают орехи, шиповник, голубика и многие другие плоды и ягоды. Отличается август и разнообразием грибов. Дело в том, что в этом месяце наступает второй слой плодоношения летних видов, а для осенних со второй половины августа при благоприятных условиях начинается первый, т. е. в августе встречаются и летние и осенние грибы. Сентябрь справедливо считают самым красивым месяцем осени — в лесу обилие плодов и щедрость красок. Неповторима тихая торжественность сентябрьского леса при полном отсутствии птичьих голосов. Если же подует ветер, лес обрушит на вас сверкающий водопад золотисто-багряных листьев. Пестрым мягким ковром покроют они лесную почву, и нелегко будет отыскать среди них осенние грибные трофеи. А грибов в это время много: в сентябре проходит третий, обычно очень обильный, слой позднелетних видов: белых грибов, подосиновиков, подберезовиков, рыжиков, волнушек, груздей и др. К ним присоединяются уже осенние грибы: рядовка фиолетовая, шампиньон лесной, моховик желто-бурый, опенок осенний.
В лесах в это время появляются грибы из очень обширного рода паутинников (в нашей стране их насчитывается свыше 400 видов). Некоторые из паутинников съедобны, например бело-фиолетовый, растущий в восточных районах, паутинник разноцветный, довольно крупный гриб (шляпка до 15 см в диаметре), который селится в хвойных и лиственных лесах Сибири, паутинник фиолетовый, тоже крупный съедобный гриб, встречающийся в сосновых лесах северных районов и средней полосы и паутинник красный с запахом редьки, растущий в хвойных лесах почти повсеместно. Необходимо отметить, что при сборе паутинников следует быть очень внимательными и осторожными, так как среди них есть и ядовитые паутинники кроваво-красный, зеленоватый и др.
Самый распространенный и обильный гриб сентября — холодолюбивый опенок осенний со шляпкой до 10 см в диаметре, растущий группами на стволах живых деревьев и кустарниках как паразит, а также на мертвой древесине как сапротроф. Гриб этот с хорошими вкусовыми качествами, употребляется для засолки, маринования, а в свежем виде для жаркого.
Колпак кольчатый
Август — самый щедрый, самый обильный плодами месяц лета: поспевают орехи, шиповник, голубика и многие другие плоды и ягоды. Отличается август и разнообразием грибов. Дело в том, что в этом месяце наступает второй слой плодоношения летних видов, а для осенних со второй половины августа при благоприятных условиях начинается первый, т. е. в августе встречаются и летние и осенние грибы. Сентябрь справедливо считают самым красивым месяцем осени — в лесу обилие плодов и щедрость красок. Неповторима тихая торжественность сентябрьского леса при полном отсутствии птичьих голосов. Если же подует ветер, лес обрушит на вас сверкающий водопад золотисто-багряных листьев. Пестрым мягким ковром покроют они лесную почву, и нелегко будет отыскать среди них осенние грибные трофеи. А грибов в это время много: в сентябре проходит третий, обычно очень обильный, слой позднелетних видов: белых грибов, подосиновиков, подберезовиков, рыжиков, волнушек, груздей и др. К ним присоединяются уже осенние грибы: рядовка фиолетовая, шампиньон лесной, моховик желто-бурый, опенок осенний.
В лесах в это время появляются грибы из очень обширного рода паутинников (в нашей стране их насчитывается свыше 400 видов). Некоторые из паутинников съедобны, например бело-фиолетовый, растущий в восточных районах, паутинник разноцветный, довольно крупный гриб (шляпка до 15 см в диаметре), который селится в хвойных и лиственных лесах Сибири, паутинник фиолетовый, тоже крупный съедобный гриб, встречающийся в сосновых лесах северных районов и средней полосы и паутинник красный с запахом редьки, растущий в хвойных лесах почти повсеместно. Необходимо отметить, что при сборе паутинников следует быть очень внимательными и осторожными, так как среди них есть и ядовитые паутинники кроваво-красный, зеленоватый и др.
Самый распространенный и обильный гриб сентября — холодолюбивый опенок осенний со шляпкой до 10 см в диаметре, растущий группами на стволах живых деревьев и кустарниках как паразит, а также на мертвой древесине как сапротроф. Гриб этот с хорошими вкусовыми качествами, употребляется для засолки, маринования, а в свежем виде для жаркого.
 Моховик желто-бурый
В сентябре и в октябре, к закрытию грибного сезона, в сыроватых сосновых и сосново-березовых лесах можно найти редкий сморчковый гриб строчок осенний с белой или слегка красноватой ножкой и каштаново-коричневой волнистой шляпкой. В обилии появляется и гриб-скороспелка навозник белый, относящийся к деликатесным, очень нежным грибам. Этот гриб молочно-белый со шляпкой 5-12 см в высоту, яйцевидной, покрытой многочисленными чешуйками, за что гриб называют еще навозником лохматым. Плодовое тело частично растет в земле и может прорасти через плотный грунт, даже асфальт. Обычно гриб поселяется на богатой перегноем, хорошо унавоженной почве в парках, садах, во дворах, на свалках, очень часто его можно встретить и на городских газонах. В отличие от многих других грибов шляпка у навозника почти не расправляется, а быстро начинает темнеть и расплываться в чернилоподобную жидкость (очень быстро происходит процесс саморазложения гриба — автолиз). Навозник съедобен лишь пока он чисто белый. Если же шляпка начала темнеть, гриб уже непригоден в пищу. Грибы эти дозревают даже будучи собранными, причем саморазложение продолжается даже в замороженных грибах. Вот почему собранные белые навозники нужно сразу же переработать, они пригодны для супов, соусов, жаркого. К концу сентября количество плодоносящих грибов резко сокращается, но в это время, а также в октябре и до самого снега можно собирать в лесу довольно обильные позднеосенние виды. К ним относятся: рядовка фиолетовая со шляпкой до 14 см в диаметре, растущая группами в хвойных лесах, которую употребляют в свежем и маринованном видах (грибники ее чаще не берут); говорушка серая, о которой мы уже упоминали; зеленушка с зеленоватой шляпкой и желтой мякотью; серушка, часто встречающаяся в это время в березовых и осиновых лесах; распространенный масленок поздний, или настоящий.
Моховик желто-бурый
В сентябре и в октябре, к закрытию грибного сезона, в сыроватых сосновых и сосново-березовых лесах можно найти редкий сморчковый гриб строчок осенний с белой или слегка красноватой ножкой и каштаново-коричневой волнистой шляпкой. В обилии появляется и гриб-скороспелка навозник белый, относящийся к деликатесным, очень нежным грибам. Этот гриб молочно-белый со шляпкой 5-12 см в высоту, яйцевидной, покрытой многочисленными чешуйками, за что гриб называют еще навозником лохматым. Плодовое тело частично растет в земле и может прорасти через плотный грунт, даже асфальт. Обычно гриб поселяется на богатой перегноем, хорошо унавоженной почве в парках, садах, во дворах, на свалках, очень часто его можно встретить и на городских газонах. В отличие от многих других грибов шляпка у навозника почти не расправляется, а быстро начинает темнеть и расплываться в чернилоподобную жидкость (очень быстро происходит процесс саморазложения гриба — автолиз). Навозник съедобен лишь пока он чисто белый. Если же шляпка начала темнеть, гриб уже непригоден в пищу. Грибы эти дозревают даже будучи собранными, причем саморазложение продолжается даже в замороженных грибах. Вот почему собранные белые навозники нужно сразу же переработать, они пригодны для супов, соусов, жаркого. К концу сентября количество плодоносящих грибов резко сокращается, но в это время, а также в октябре и до самого снега можно собирать в лесу довольно обильные позднеосенние виды. К ним относятся: рядовка фиолетовая со шляпкой до 14 см в диаметре, растущая группами в хвойных лесах, которую употребляют в свежем и маринованном видах (грибники ее чаще не берут); говорушка серая, о которой мы уже упоминали; зеленушка с зеленоватой шляпкой и желтой мякотью; серушка, часто встречающаяся в это время в березовых и осиновых лесах; распространенный масленок поздний, или настоящий.
 Приболотник (паутинник) желтый
Самые поздние виды грибов это, пожалуй, гигрофор бурый, или мокрица бурая, с оливковой или оливково-коричневой шляпкой, растущий в хвойных лесах и встречающийся даже в ноябре после заморозков, и зимний гриб или фламмулина бархатистая с желтой шляпкой и хрящеватой коричневой ножкой, называемая еще зимним опенком. Растет зимний опенок большими группами на пнях и валеже лиственных деревьев, а также на живых деревьях, особенно часто на осине, тополях и ивах. В южных районах нашей страны этот вкусный съедобный гриб не сходит до декабря. Его можно искусственно выращивать на смеси опилок и отрубей.
Приболотник (паутинник) желтый
Самые поздние виды грибов это, пожалуй, гигрофор бурый, или мокрица бурая, с оливковой или оливково-коричневой шляпкой, растущий в хвойных лесах и встречающийся даже в ноябре после заморозков, и зимний гриб или фламмулина бархатистая с желтой шляпкой и хрящеватой коричневой ножкой, называемая еще зимним опенком. Растет зимний опенок большими группами на пнях и валеже лиственных деревьев, а также на живых деревьях, особенно часто на осине, тополях и ивах. В южных районах нашей страны этот вкусный съедобный гриб не сходит до декабря. Его можно искусственно выращивать на смеси опилок и отрубей.
 Строчок осенний
Всего в средней полосе нашей страны насчитывается более 200 видов съедобных грибов, и мы перечислили далеко не все виды, остановились в основном на наиболее обильно плодоносящих и малоизвестных съедобных грибах и наиболее опасных ядовитых.
Строчок осенний
Всего в средней полосе нашей страны насчитывается более 200 видов съедобных грибов, и мы перечислили далеко не все виды, остановились в основном на наиболее обильно плодоносящих и малоизвестных съедобных грибах и наиболее опасных ядовитых.
 Строфария сине-зеленая
Из приведенного обзора видно, что число видов и обилие плодоношения грибов начинает интенсивно увеличиваться во второй половине июля и достигает максимума в середине августа или первой декаде сентября, а затем падает, причем наибольшее видовое разнообразие приходится на конец августа — начало сентября. Анализ фенологических сроков появления и основного плодоношения грибов (второй и третий слои) свидетельствует о том, что сроки могут смещаться по годам на 10-15 дней, в зависимости от метеорологических факторов, причем значение имеет сочетание количества осадков, влажности, температуры воздуха и типов леса. Если, например, в начале сентября надолго зарядили дожди, то в слишком насыщенной водой почве недостаточно воздуха и плодовые тела не появятся.
Строфария сине-зеленая
Из приведенного обзора видно, что число видов и обилие плодоношения грибов начинает интенсивно увеличиваться во второй половине июля и достигает максимума в середине августа или первой декаде сентября, а затем падает, причем наибольшее видовое разнообразие приходится на конец августа — начало сентября. Анализ фенологических сроков появления и основного плодоношения грибов (второй и третий слои) свидетельствует о том, что сроки могут смещаться по годам на 10-15 дней, в зависимости от метеорологических факторов, причем значение имеет сочетание количества осадков, влажности, температуры воздуха и типов леса. Если, например, в начале сентября надолго зарядили дожди, то в слишком насыщенной водой почве недостаточно воздуха и плодовые тела не появятся.
 Рядовка фиолетовая
Грибы значительно различаются не только по срокам появления, но и по характеру плодоношения. Подберезовики и подосиновики плодоносят достаточно долго, с июня по сентябрь, и слои плодоношения у них выражены не очень четко. Рыжики, грузди и осенние опенки плодоносят короткий период, со второй половины августа до конца сентября, давая за это время один-два очень значительных по обилию плодоношения слоя; иногда обильное плодоношение этих грибов длится всего несколько дней.
Рядовка фиолетовая
Грибы значительно различаются не только по срокам появления, но и по характеру плодоношения. Подберезовики и подосиновики плодоносят достаточно долго, с июня по сентябрь, и слои плодоношения у них выражены не очень четко. Рыжики, грузди и осенние опенки плодоносят короткий период, со второй половины августа до конца сентября, давая за это время один-два очень значительных по обилию плодоношения слоя; иногда обильное плодоношение этих грибов длится всего несколько дней.
 Гигрофор бурый
Обычно при сборе грибов посещают одни и те же места, причем места эти посещают многие грибники, поскольку грибные секреты сохранить трудно. Возможность такого интенсивного сбора грибов в одном месте обусловлена ежедневным появлением при благоприятных погодных условиях новых плодовых тел и их быстрым ростом. Надо помнить, что в теплую, но не жаркую погоду грибы растут быстрее, чем в холодную. К тому же опытный грибник знает, что в сухую погоду грибы родятся ближе к стволу дерева, как бы прячутся в тени, и в это время искать их лучше под низкими лапами молодых елей или в густой траве. Если же прошли обильные дожди и температура понизилась, грибы как бы выбегают из тени стволов на полянки, ближе к свету и теплу.
Гигрофор бурый
Обычно при сборе грибов посещают одни и те же места, причем места эти посещают многие грибники, поскольку грибные секреты сохранить трудно. Возможность такого интенсивного сбора грибов в одном месте обусловлена ежедневным появлением при благоприятных погодных условиях новых плодовых тел и их быстрым ростом. Надо помнить, что в теплую, но не жаркую погоду грибы растут быстрее, чем в холодную. К тому же опытный грибник знает, что в сухую погоду грибы родятся ближе к стволу дерева, как бы прячутся в тени, и в это время искать их лучше под низкими лапами молодых елей или в густой траве. Если же прошли обильные дожди и температура понизилась, грибы как бы выбегают из тени стволов на полянки, ближе к свету и теплу.
 Зеленушка
Грибнику следует также знать некоторые особенности грибов, что может в значительной степени облегчить их поиски. Необходимо, например, знать, что для грибов требуется достаточно питательная среда, оптимальные влажность и температура воздуха, а для некоторых видов еще и степень освещенности. Лучше всего грибы растут там, где имеется достаточное количество органических остатков, поэтому прохладные, в меру сырые леса, с развитым моховым и лишайниковым покровом наиболее подходящи для них.
Наибольшее количество видов грибов встречается в смешанных лесах, много грибов можно найти на лесных опушках и по краям лесных тропинок и дорог.
Что касается урожайности грибов, то многолетний опыт показывает, что в средних широтах главное значение для урожая грибов имеют осадки, причем августовские; июльские же, выпавшие при высоких температурах, и сентябрьские — при пониженных существенного значения для урожая грибов не имеют. Вместе с тем при изобилии осадков в августе и значительном количестве их в сентябре при сравнительно низкой температуре в июле и августе грибы урожая тоже не дадут. Следовательно, для выявления зависимости между урожаями грибов и средними данными температуры и осадков последние необходимо брать помесячно, а еще лучше подекадно. Средние за весь вегетационный период осадки непоказательны. Отсюда следует, что для урожайности грибов наибольшее значение имеет погода, а не климат в целом. Итак, почти в любое время года, кроме зимы и ранней весны, грибник-любитель найдет в лесу грибные трофеи, и чем труднее их отыскать ранней весной или поздней осенью, тем они нам дороже. Этим сбор грибов приближается к другим видам охот, поскольку требует и знаний, и наблюдательности, и умения ориентироваться. При таком подходе сбор грибов из простой заготовительной операции превращается в приятное и полезное занятие, позволяющее более пристально всмотреться в родную природу, глубже и лучше познать ее.
Зеленушка
Грибнику следует также знать некоторые особенности грибов, что может в значительной степени облегчить их поиски. Необходимо, например, знать, что для грибов требуется достаточно питательная среда, оптимальные влажность и температура воздуха, а для некоторых видов еще и степень освещенности. Лучше всего грибы растут там, где имеется достаточное количество органических остатков, поэтому прохладные, в меру сырые леса, с развитым моховым и лишайниковым покровом наиболее подходящи для них.
Наибольшее количество видов грибов встречается в смешанных лесах, много грибов можно найти на лесных опушках и по краям лесных тропинок и дорог.
Что касается урожайности грибов, то многолетний опыт показывает, что в средних широтах главное значение для урожая грибов имеют осадки, причем августовские; июльские же, выпавшие при высоких температурах, и сентябрьские — при пониженных существенного значения для урожая грибов не имеют. Вместе с тем при изобилии осадков в августе и значительном количестве их в сентябре при сравнительно низкой температуре в июле и августе грибы урожая тоже не дадут. Следовательно, для выявления зависимости между урожаями грибов и средними данными температуры и осадков последние необходимо брать помесячно, а еще лучше подекадно. Средние за весь вегетационный период осадки непоказательны. Отсюда следует, что для урожайности грибов наибольшее значение имеет погода, а не климат в целом. Итак, почти в любое время года, кроме зимы и ранней весны, грибник-любитель найдет в лесу грибные трофеи, и чем труднее их отыскать ранней весной или поздней осенью, тем они нам дороже. Этим сбор грибов приближается к другим видам охот, поскольку требует и знаний, и наблюдательности, и умения ориентироваться. При таком подходе сбор грибов из простой заготовительной операции превращается в приятное и полезное занятие, позволяющее более пристально всмотреться в родную природу, глубже и лучше познать ее.
Искусственное выращивание грибов
 Выращивание грибов — развивающаяся перспективная отрасль сельского хозяйства
Вопрос о возможности искусственного выращивания съедобных грибов уже свыше двух тысячелетий занимает человечество, однако по отношению к большинству видов грибов он до настоящего времени еще далеко не разрешен.
Интенсивное ведение лесного хозяйства, развитие деревообрабатывающей промышленности, растущее потребление древесины для строительства и сельского хозяйства повлекли за собой сокращение площади леса, а загрязнение промышленными и бытовыми отходами окружающей среды отрицательно повлияло на урожайность дикорастущих грибов, отличающихся повышенной чувствительностью к составу субстрата.
В связи с меняющимися требованиями к рациону питания людей потребность в грибных продуктах постоянно увеличивается, что делает необходимым расширение культуры грибов, поскольку они, обладая высоким содержанием белков, витаминов, экстрактивных и минеральных веществ, все более отвечают современным требованиям калорийности и содержания питания. Положение с обеспечением продуктами питания на нашей планете в настоящее время не везде одинаковое. Статистические данные ФАО ООН свидетельствуют о том, что более половины населения нашей планеты не обеспечены достаточным количеством продуктов питания, примерно 500 млн. людей голодают, а около 2 млрд. питаются недостаточно или неправильно.
Взрослому человеку при легкой физической работе достаточно 3000 ккал в сутки, которые содержатся в 330 г подсолнечного масла или в 750 г сахара. Однако удовлетворить потребность организма за счет только масла или сахара практически невозможно, ибо пища доставляет нам не только энергию для работы, но еще и материал для роста и обновления тканей и клеток. Поэтому она должна быть разнообразной и содержать белки, жиры, углеводы и витамины. Источник энергии (жиры и углеводы) в определенных пределах можно заменять друг другом или белками, но белки незаменимы. Проблема питания людей в конечном счете заключается в дефиците белка (по самым скромным подсчетам ежегодный дефицит белка оценивается в 15 млн. т!).
Решить эту проблему можно, только используя все имеющиеся у людей средства и изыскав новые источники получения продуктов питания, среди которых наряду с продуктами морей и океанов важное место займут грибы.
Подсчитано, что примерная оценка выхода говядины при ее производстве современными методами составляет приблизительно 63,5 кг сухого белка на 1 га в год, а рыбоводство, являющееся новым развивающимся методом производства белка, может дать в год 567,5 кг с такой же площади. Многие грибоводческие предприятия уже в настоящее время получают 67-78 т сухого белка с 1 га обрабатываемой поверхности в год! Не здесь ли таятся главные новые источники белка для удовлетворения потребностей в связи с ростом мирового населения? Это обстоятельство и побудило многие страны к созданию национальных программ по изучению возможностей производства белков.
Перед людьми во всем мире сейчас существуют две очень важные проблемы: увеличение производства продуктов питания на душу населения и проблема удаления отходов. На отходах сельского хозяйства выращиваются грибы — шампиньоны, вешенки, зимний опенок, вольварелла и др. Таким образом, эта отрасль промышленности способна решать обе эти задачи — одновременно увеличивать количество продуктов питания и использовать отходы.
Сделать грибы такой же управляемой сельскохозяйственной культурой, как зерновые злаки, овощи и фрукты, давно уже было очень соблазнительной задачей для людей, решить которую, однако, оказалось значительно сложнее, чем это можно было предполагать вначале. До нас дошли сведения о том, что древние греки, вошедшие в историю, помимо всего прочего, еще и как большие гурманы, владели познаниями в технологии выращивания некоторых древоразрушающих грибов, однако эта отрасль широкого развития у них не получила, и потомки их скоро о ней забыли.
Искусственное разведение древоразрушающих грибов получило широкое распространение преимущественно в странах Юго-Восточной Азии, причем насчитывает оно свыше 2000 лет, а технологические секреты культуры передавались грибоводами из поколения в поколение.
Выращивание грибов — развивающаяся перспективная отрасль сельского хозяйства
Вопрос о возможности искусственного выращивания съедобных грибов уже свыше двух тысячелетий занимает человечество, однако по отношению к большинству видов грибов он до настоящего времени еще далеко не разрешен.
Интенсивное ведение лесного хозяйства, развитие деревообрабатывающей промышленности, растущее потребление древесины для строительства и сельского хозяйства повлекли за собой сокращение площади леса, а загрязнение промышленными и бытовыми отходами окружающей среды отрицательно повлияло на урожайность дикорастущих грибов, отличающихся повышенной чувствительностью к составу субстрата.
В связи с меняющимися требованиями к рациону питания людей потребность в грибных продуктах постоянно увеличивается, что делает необходимым расширение культуры грибов, поскольку они, обладая высоким содержанием белков, витаминов, экстрактивных и минеральных веществ, все более отвечают современным требованиям калорийности и содержания питания. Положение с обеспечением продуктами питания на нашей планете в настоящее время не везде одинаковое. Статистические данные ФАО ООН свидетельствуют о том, что более половины населения нашей планеты не обеспечены достаточным количеством продуктов питания, примерно 500 млн. людей голодают, а около 2 млрд. питаются недостаточно или неправильно.
Взрослому человеку при легкой физической работе достаточно 3000 ккал в сутки, которые содержатся в 330 г подсолнечного масла или в 750 г сахара. Однако удовлетворить потребность организма за счет только масла или сахара практически невозможно, ибо пища доставляет нам не только энергию для работы, но еще и материал для роста и обновления тканей и клеток. Поэтому она должна быть разнообразной и содержать белки, жиры, углеводы и витамины. Источник энергии (жиры и углеводы) в определенных пределах можно заменять друг другом или белками, но белки незаменимы. Проблема питания людей в конечном счете заключается в дефиците белка (по самым скромным подсчетам ежегодный дефицит белка оценивается в 15 млн. т!).
Решить эту проблему можно, только используя все имеющиеся у людей средства и изыскав новые источники получения продуктов питания, среди которых наряду с продуктами морей и океанов важное место займут грибы.
Подсчитано, что примерная оценка выхода говядины при ее производстве современными методами составляет приблизительно 63,5 кг сухого белка на 1 га в год, а рыбоводство, являющееся новым развивающимся методом производства белка, может дать в год 567,5 кг с такой же площади. Многие грибоводческие предприятия уже в настоящее время получают 67-78 т сухого белка с 1 га обрабатываемой поверхности в год! Не здесь ли таятся главные новые источники белка для удовлетворения потребностей в связи с ростом мирового населения? Это обстоятельство и побудило многие страны к созданию национальных программ по изучению возможностей производства белков.
Перед людьми во всем мире сейчас существуют две очень важные проблемы: увеличение производства продуктов питания на душу населения и проблема удаления отходов. На отходах сельского хозяйства выращиваются грибы — шампиньоны, вешенки, зимний опенок, вольварелла и др. Таким образом, эта отрасль промышленности способна решать обе эти задачи — одновременно увеличивать количество продуктов питания и использовать отходы.
Сделать грибы такой же управляемой сельскохозяйственной культурой, как зерновые злаки, овощи и фрукты, давно уже было очень соблазнительной задачей для людей, решить которую, однако, оказалось значительно сложнее, чем это можно было предполагать вначале. До нас дошли сведения о том, что древние греки, вошедшие в историю, помимо всего прочего, еще и как большие гурманы, владели познаниями в технологии выращивания некоторых древоразрушающих грибов, однако эта отрасль широкого развития у них не получила, и потомки их скоро о ней забыли.
Искусственное разведение древоразрушающих грибов получило широкое распространение преимущественно в странах Юго-Восточной Азии, причем насчитывает оно свыше 2000 лет, а технологические секреты культуры передавались грибоводами из поколения в поколение.
Сиитаке
 Сиитаке — гриб, который очень любят и выращивают на деревьях в Японии и других странах Дальнего Востока
Наиболее распространенной культурой на Дальнем Востоке стал древоразрушающий гриб, называемый у нас сиитаке и встречающийся в естественных условиях в Китае, Японии, Малайзии и на Филиппинах на дубе и грабе.
Сиитаке и до сих пор искусственно выращивается в Японии, в Южной Корее, в Китае и на Тайване, причем масштабы его производства увеличиваются с каждым годом и уже достигли 130 тыс. т в год. Более десятилетия грибы вида сиитаке являются одним из важнейших сельскохозяйственных экспортных продуктов Японии. В сушеном виде их отправляют во Францию, ФРГ, США и Англию, т. е. в страны с несравненно большими экспортными возможностями сельского хозяйства.
Сиитаке развивается и образует плодовое тело на древесине лиственных деревьев. Для его развития необходима температура 12-20oС и высокая влажность; создание таких условий при современных методах грибоводства большого труда и особых затрат не требует. Плантации сиитаке устраивают на открытом воздухе в затененных местах. В последнее время очень хорошие результаты получаются при выращивании этого гриба в теплицах и других помещениях.
Для разведения сиитаке распиливают поваленные для этого деревья на отдельные бруски и заражают мицелием гриба, после чего бруски устанавливают наклонно — в таком положении древесина прорастает грибницей. Первые плодовые тела появляются через 2 года при наличии дождей. Общая длительность сбора грибов до 6 лет, причем с 1 м3 древесины за 5-6 лет снимают около 240 кг сырых грибов.
В связи с успешной разработкой метода выращивания сиитаке в закрытых помещениях на опилках с различными добавками и на рисовой соломе, смоченной экстрактом из соевых бобов, культивирование этих грибов существенно упростилось, перестало зависеть от погодных условий, поэтому выращивать сиитаке сейчас пробуют в странах Европы — ФРГ, Италии, Австрии.
Следует отметить, что свыше 70 стран Европы, Азии, Северной и Южной Америки, Африки и Австралии сейчас выращивают съедобные грибы; мировое производство их возросло с 60 тыс. т в 1950 г. до 900 тыс. т в 1980 г. Себестоимость производства 1 кг культивируемых грибов в переводе на рубли по курсу колеблется в отдельных странах от 40 до 90 к. .
Искусственное разведение грибов имеет, однако, естественное препятствие, преодолеть которое смогут, по-видимому, только микологи будущего с иным, более высоким уровнем знания физиологии и генетики грибов и особенностей их развития. Дело в том, что наиболее ценные съедобные грибы, такие, как белый, подберезовик, цезарский гриб, подосиновик и др., искусственное разведение которых представляло бы наибольший интерес, относятся к группе микоризных грибов и их культура в искусственных условиях без наличия соответствующих пород деревьев до последнего времени не представлялась возможной. Правда, в России предпринимались попытки разводить различные лесные деликатесные грибы — рыжики, подберезовики и белые; но попытки эти не имели производственного значения, не получили сколько-нибудь широкого распространения и теоретического обоснования. Способ разведения этих грибов был весьма примитивен и заключался в том, что на садовый участок, засаженный соответствующими породами деревьев (елью, березой и т. д.), переносили дикорастущую грибницу или это место поливали настоем, приготовленным из созревших плодовых тел. В некоторых местах таким способом действительно удавалось выращивать микоризные грибы, но все это имело значение лишь для грибоводов-любителей.
Ряд работ последних лет показал, что в искусственных условиях при отсутствии корней деревьев все же можно получать плодовые тела микоризных грибов. И хотя до промышленного производства этих грибов еще очень далеко, освоение метода их культивирования в лабораторных условиях открывает возможности для дальнейшего изучения их биологии, что безусловно является решающей предпосылкой для их широкого культивирования в будущем. А пока из всей группы микоризных грибов только культура черного, или французского, трюфеля получила широкое распространение еще с середины XVIII в. во Франции и несколько позже на юге Германии.
Сиитаке — гриб, который очень любят и выращивают на деревьях в Японии и других странах Дальнего Востока
Наиболее распространенной культурой на Дальнем Востоке стал древоразрушающий гриб, называемый у нас сиитаке и встречающийся в естественных условиях в Китае, Японии, Малайзии и на Филиппинах на дубе и грабе.
Сиитаке и до сих пор искусственно выращивается в Японии, в Южной Корее, в Китае и на Тайване, причем масштабы его производства увеличиваются с каждым годом и уже достигли 130 тыс. т в год. Более десятилетия грибы вида сиитаке являются одним из важнейших сельскохозяйственных экспортных продуктов Японии. В сушеном виде их отправляют во Францию, ФРГ, США и Англию, т. е. в страны с несравненно большими экспортными возможностями сельского хозяйства.
Сиитаке развивается и образует плодовое тело на древесине лиственных деревьев. Для его развития необходима температура 12-20oС и высокая влажность; создание таких условий при современных методах грибоводства большого труда и особых затрат не требует. Плантации сиитаке устраивают на открытом воздухе в затененных местах. В последнее время очень хорошие результаты получаются при выращивании этого гриба в теплицах и других помещениях.
Для разведения сиитаке распиливают поваленные для этого деревья на отдельные бруски и заражают мицелием гриба, после чего бруски устанавливают наклонно — в таком положении древесина прорастает грибницей. Первые плодовые тела появляются через 2 года при наличии дождей. Общая длительность сбора грибов до 6 лет, причем с 1 м3 древесины за 5-6 лет снимают около 240 кг сырых грибов.
В связи с успешной разработкой метода выращивания сиитаке в закрытых помещениях на опилках с различными добавками и на рисовой соломе, смоченной экстрактом из соевых бобов, культивирование этих грибов существенно упростилось, перестало зависеть от погодных условий, поэтому выращивать сиитаке сейчас пробуют в странах Европы — ФРГ, Италии, Австрии.
Следует отметить, что свыше 70 стран Европы, Азии, Северной и Южной Америки, Африки и Австралии сейчас выращивают съедобные грибы; мировое производство их возросло с 60 тыс. т в 1950 г. до 900 тыс. т в 1980 г. Себестоимость производства 1 кг культивируемых грибов в переводе на рубли по курсу колеблется в отдельных странах от 40 до 90 к. .
Искусственное разведение грибов имеет, однако, естественное препятствие, преодолеть которое смогут, по-видимому, только микологи будущего с иным, более высоким уровнем знания физиологии и генетики грибов и особенностей их развития. Дело в том, что наиболее ценные съедобные грибы, такие, как белый, подберезовик, цезарский гриб, подосиновик и др., искусственное разведение которых представляло бы наибольший интерес, относятся к группе микоризных грибов и их культура в искусственных условиях без наличия соответствующих пород деревьев до последнего времени не представлялась возможной. Правда, в России предпринимались попытки разводить различные лесные деликатесные грибы — рыжики, подберезовики и белые; но попытки эти не имели производственного значения, не получили сколько-нибудь широкого распространения и теоретического обоснования. Способ разведения этих грибов был весьма примитивен и заключался в том, что на садовый участок, засаженный соответствующими породами деревьев (елью, березой и т. д.), переносили дикорастущую грибницу или это место поливали настоем, приготовленным из созревших плодовых тел. В некоторых местах таким способом действительно удавалось выращивать микоризные грибы, но все это имело значение лишь для грибоводов-любителей.
Ряд работ последних лет показал, что в искусственных условиях при отсутствии корней деревьев все же можно получать плодовые тела микоризных грибов. И хотя до промышленного производства этих грибов еще очень далеко, освоение метода их культивирования в лабораторных условиях открывает возможности для дальнейшего изучения их биологии, что безусловно является решающей предпосылкой для их широкого культивирования в будущем. А пока из всей группы микоризных грибов только культура черного, или французского, трюфеля получила широкое распространение еще с середины XVIII в. во Франции и несколько позже на юге Германии.
Черный трюфель
 Знаменитый черный французский трюфель
Для культивирования черного трюфеля использовали естественно растущие и искусственно насаженные дубовые и буковые рощи.
Этот гриб имеет сильный и стойкий аромат и нежный вкус, в силу чего всегда по достоинству высоко ценился гастрономами. В популярной литературе его часто называют "черным бриллиантом". Сейчас французский трюфель считается одним из самых деликатесных блюд и очень высоко ценится на мировом рынке. Плодовое тело гриба подземное, округлое с неровной бугристой поверхностью черного цвета, размером от грецкого ореха до яблока средних размеров, мякоть красноватая, при созревании фиолетово-черная. Созревает трюфель осенью и собирают его до самой зимы. Он образует микоризу с дубом, буком, грабом и орешником. Для успешного роста трюфелей нужна известковая щебнистая почва и довольно теплый климат. Такие условия имеются на юге Франции и в Северной Италии; изредка черный трюфель находят в южных районах ФРГ.
Искусственное разведение французских трюфелей сводится, по существу, к закладке новых дубовых плантаций, причем в почву добавляют некоторое количество земли, взятой из районов естественных мест обитания этих грибов, содержащей в себе его споры и грибницу. Тщательный, установившийся десятилетиями уход за такой плантацией обеспечивает появление урожая трюфелей примерно через 6-7 лет после посадки, плодоношение продолжается 25-30 лет.
В природе известно более 50 видов трюфелей, однако с промышленной точки зрения значение имеют только 2 вида: черный и белый, из которых первый относится к деликатесным грибам и поэтому разводится искусственно. Главным производителем черных трюфелей является Франция, где ежегодно производится 100-200 т этих грибов; имеются сведения о том, что в отдельные годы урожаи черного трюфеля достигают 800 т. Интересно отметить, что если в 1892 г. их было собрано (дикорастущих и с плантаций) 2 тыс. т, то в 1970 г. в 20 раз меньше, всего 100 т. Во Франции есть фирма, производящая микоризные сеянцы, которыми снабжаются специальные хозяйства; в связи с этим во Франции да и в других странах, производящих трюфели, сейчас отпала необходимость в переноске естественной грибницы.
Плодовые тела черного трюфеля располагаются в почве гнездами по 3-7 шт., причем при созревании они немного приподнимают почву, а трава в районе гнезд обычно засыхает, что и служит сигналом к началу сбора урожая. Раньше трюфели собирали с помощью дрессированных свиней и собак. Имеется даже вышедшее в начале нашего века руководство по сбору трюфелей дрессированными домашними животными, которые содержат в себе следующие рекомендации: "Для искания трюфелей со свиньями употребляются как самцы, так и самки, но последние предпочитаются как более выгодные благодаря ежегодному приплоду. Для этой цели пригодны свиньи всякой породы, лишь бы они были послушны, достаточно поворотливы и обладали острым чутьем. В целях лучшего развития чутья, которое передается наследственно, обыкновенно стараются брать свиней от производителей, уже занимающихся трюфелеисканием, и, кроме того, подвергают их предварительной дрессировке, заставляя отыскивать спрятанные в земле кусочки трюфеля". "Собаки для охоты за трюфелями употребляются различных пород, но преимущественно низкорослые, отнюдь не охотничьи, так как последние часто отвлекаются от трюфелей погоней за дичью. Для того чтобы приучить собаку к отыскиванию трюфелей, в течение некоторого времени ее держат "на диете" идают лишь небольшие куски хлеба с примесью трюфелей, а перед отправлением в лес на некоторое время и совсем лишают пищи".
В настоящее время трюфели собирают, используя так называемых "трюфельных мух", которые откладывают свои яички около трюфелей, так как их личинки питаются этими грибами. Заметив место, где над слегка приподнятой почвой вьются мелкие мухи, сборщики начинают осторожно раскапывать почву и достают ценный гриб. В таком виде эта культура ведется во Франции, однако по имеющимся данным, производство трюфелей становится нерентабельным, в силу чего ведутся исследования с целью интенсификации этой культуры и сокращения ее себестоимости. Однако урожаи черного трюфеля продолжают падать, и если в 1983 г. во Франции их было собрано 45 т, то в 1984 г. всего 10 т, в результате чего их стоимость достигла рекордного уровня, более 400 долларов за 1 кг.
Подобным способом в рощах и яблоневых садах разводят и сморчковые грибы, в основном сморчок конический. Для его выращивания используют гряды, приготовленные под деревьями. На грядах, раскладываются кусочки зрелых плодовых тел сморчков, сверху присыпают рыхлой почвой (рекомендуется также присыпать их древесной золой), а на зиму укрывают слоем сухой листвы березы или бука и еловым лапником. Весной грибы на грядах начинают плодоносить, и урожай можно собирать в течение нескольких лет. Сморчки предпочитают только песчаную почву, а глинистая почва для них непригодна.
В настоящее время искусственным разведением сморчков у нас в стране занимаются только лишь немногие грибоводы-любители.
Знаменитый черный французский трюфель
Для культивирования черного трюфеля использовали естественно растущие и искусственно насаженные дубовые и буковые рощи.
Этот гриб имеет сильный и стойкий аромат и нежный вкус, в силу чего всегда по достоинству высоко ценился гастрономами. В популярной литературе его часто называют "черным бриллиантом". Сейчас французский трюфель считается одним из самых деликатесных блюд и очень высоко ценится на мировом рынке. Плодовое тело гриба подземное, округлое с неровной бугристой поверхностью черного цвета, размером от грецкого ореха до яблока средних размеров, мякоть красноватая, при созревании фиолетово-черная. Созревает трюфель осенью и собирают его до самой зимы. Он образует микоризу с дубом, буком, грабом и орешником. Для успешного роста трюфелей нужна известковая щебнистая почва и довольно теплый климат. Такие условия имеются на юге Франции и в Северной Италии; изредка черный трюфель находят в южных районах ФРГ.
Искусственное разведение французских трюфелей сводится, по существу, к закладке новых дубовых плантаций, причем в почву добавляют некоторое количество земли, взятой из районов естественных мест обитания этих грибов, содержащей в себе его споры и грибницу. Тщательный, установившийся десятилетиями уход за такой плантацией обеспечивает появление урожая трюфелей примерно через 6-7 лет после посадки, плодоношение продолжается 25-30 лет.
В природе известно более 50 видов трюфелей, однако с промышленной точки зрения значение имеют только 2 вида: черный и белый, из которых первый относится к деликатесным грибам и поэтому разводится искусственно. Главным производителем черных трюфелей является Франция, где ежегодно производится 100-200 т этих грибов; имеются сведения о том, что в отдельные годы урожаи черного трюфеля достигают 800 т. Интересно отметить, что если в 1892 г. их было собрано (дикорастущих и с плантаций) 2 тыс. т, то в 1970 г. в 20 раз меньше, всего 100 т. Во Франции есть фирма, производящая микоризные сеянцы, которыми снабжаются специальные хозяйства; в связи с этим во Франции да и в других странах, производящих трюфели, сейчас отпала необходимость в переноске естественной грибницы.
Плодовые тела черного трюфеля располагаются в почве гнездами по 3-7 шт., причем при созревании они немного приподнимают почву, а трава в районе гнезд обычно засыхает, что и служит сигналом к началу сбора урожая. Раньше трюфели собирали с помощью дрессированных свиней и собак. Имеется даже вышедшее в начале нашего века руководство по сбору трюфелей дрессированными домашними животными, которые содержат в себе следующие рекомендации: "Для искания трюфелей со свиньями употребляются как самцы, так и самки, но последние предпочитаются как более выгодные благодаря ежегодному приплоду. Для этой цели пригодны свиньи всякой породы, лишь бы они были послушны, достаточно поворотливы и обладали острым чутьем. В целях лучшего развития чутья, которое передается наследственно, обыкновенно стараются брать свиней от производителей, уже занимающихся трюфелеисканием, и, кроме того, подвергают их предварительной дрессировке, заставляя отыскивать спрятанные в земле кусочки трюфеля". "Собаки для охоты за трюфелями употребляются различных пород, но преимущественно низкорослые, отнюдь не охотничьи, так как последние часто отвлекаются от трюфелей погоней за дичью. Для того чтобы приучить собаку к отыскиванию трюфелей, в течение некоторого времени ее держат "на диете" идают лишь небольшие куски хлеба с примесью трюфелей, а перед отправлением в лес на некоторое время и совсем лишают пищи".
В настоящее время трюфели собирают, используя так называемых "трюфельных мух", которые откладывают свои яички около трюфелей, так как их личинки питаются этими грибами. Заметив место, где над слегка приподнятой почвой вьются мелкие мухи, сборщики начинают осторожно раскапывать почву и достают ценный гриб. В таком виде эта культура ведется во Франции, однако по имеющимся данным, производство трюфелей становится нерентабельным, в силу чего ведутся исследования с целью интенсификации этой культуры и сокращения ее себестоимости. Однако урожаи черного трюфеля продолжают падать, и если в 1983 г. во Франции их было собрано 45 т, то в 1984 г. всего 10 т, в результате чего их стоимость достигла рекордного уровня, более 400 долларов за 1 кг.
Подобным способом в рощах и яблоневых садах разводят и сморчковые грибы, в основном сморчок конический. Для его выращивания используют гряды, приготовленные под деревьями. На грядах, раскладываются кусочки зрелых плодовых тел сморчков, сверху присыпают рыхлой почвой (рекомендуется также присыпать их древесной золой), а на зиму укрывают слоем сухой листвы березы или бука и еловым лапником. Весной грибы на грядах начинают плодоносить, и урожай можно собирать в течение нескольких лет. Сморчки предпочитают только песчаную почву, а глинистая почва для них непригодна.
В настоящее время искусственным разведением сморчков у нас в стране занимаются только лишь немногие грибоводы-любители.
Шампиньоны
Основной сельско-хозяйственной грибной культурой стал шампиньон двуспорый. В настоящее время его выращивают более чем в 60 странах, причем производство шампиньонов достигает 800 тыс. в год (в настоящее время ежегодно выращивается 900-1100 тыс. разных видов грибов). Чем же вызван такой интерес к выращиванию шампиньонов? Столь широкому его распространению способствовали две причины: во-первых, шампиньон как почвенный сапротроф не требует для своего развития древесной породы, что совершенно необходимо микоризным грибам. Это обстоятельство дает возможность выращивать шампиньоны в теплицах, заброшенных каменоломнях и специализированных помещениях — шампиньонницах, где, изменяя условия среды — температуру, влажность, состав субстрата, можно управлять ростом и развитием грибов, улучшая качество продуктов и увеличивая их урожайность. Во-вторых, развитию шампиньоноводства способствовала быстрая разработка, получение и широкое применение качественного посадочного материала — стерильной грибницы. Сейчас уже просто невозможно установить, когда и где впервые стали заниматься разведением шампиньонов. Предполагается, что первоначально эта культура возникла в Италии, откуда проникла во Францию. Там она должным образом была оценена гастрономами и получила широкое распространение, о чем свидетельствует указание во французском руководстве по садоводству, относящемся к середине XVII в. Таким образом, шампиньоны культивируют уже более 300 лет. В XVII-XIX вв. наибольшее развитие промышленное выращивание шампиньонов получило во Франции, особенно в окрестностях Парижа, чему в немалой степени способствовало наличие там старых заброшенных каменоломен, из которых когда-то брали камень для постройки столицы Франции. В этих каменоломнях в течение всего года сохраняется стабильная температура 12-14°С, чрезвычайно благоприятная для роста шампиньонов, и, таким образом, здесь имелись готовые помещения с подходящими для выращивания шампиньонов условиями. Следует отметить, что и сейчас эти бывшие каменоломни, лишь немного усовершенствованные, успешно используются для выращивания шампиньонов. Шампиньоны в каменоломнях под Парижем
Из Франции культура шампиньонов в XVIII в. перешла в Англию, в Германию и другие страны Европы, а также в США. В середине XVIII в. эти грибы начали выращивать и в России. Впервые вопрос о культивировании здесь шампиньонов обсуждался в статье агронома А. Болотова, опубликовавшего в 1778 г. в журнале "Экономический магазин" статью "О шампиньонах", где он делился своим опытом выращивания этих грибов в подвалах. Однако деятельность Болотова носила больше характер любительских поисков. Промышленным выращиванием шампиньонов в России начал заниматься начиная с 1848 г. петербургский огородник Е.А.Грачев. Из провинциальной прессы XIX в. до нас дошли также сведения о том, что еще в 20-х годах прошлого века в небольших количествах выращивал шампиньоны для продажи крестьянин Осинин из Ростовского уезда.
В то время шампиньоны выращивали в подвалах и в специально оборудованных теплицах, или шампиньонницах, похожих на блиндажи, где на полу или на двух-или трехъярусных стеллажах устраивали гряды из специально подготовленного конского навоза. Вначале гряды заражались грибницей, взятой с мест, где шампиньоны росли обильно в естественных условиях. Пересаженная грибница, естественно, была не стерильной, вместе с ней в шампиньонницы заносились вредители и болезни шампиньонов, поэтому урожаи культивируемых шампиньонов были весьма скромными, вполне удовлетворительным считался урожай в 4 кг с 1 м2 гряды. В 1861 г. в окрестностях Петербурга было устроено 10 шампиньонных теплиц, а к 1900 г. их уже насчитывалось около 100.
В отличие от петербургских огородников московские огородники предпочли иной тип шампиньонных теплиц — комбинированные для выгонки шампиньонов и для выгонки зелени и овощей. Дело в том, что в Москве, где влияние французской кухни было значительно слабее, шампиньоны пользовались меньшим спросом, тем более, что природные условия здесь были благоприятны для естественного роста таких первоклассных грибов, как белый, подберезовик и др.
В начале XX в., когда научились уже выращивать стерильную грибницу шампиньона в лабораториях и стали употреблять ее для посадки гряд, урожаи шампиньонов резко повысились и сократились потери от болезней и вредителей. Поскольку эта культура стала приносить стабильные доходы, она стала быстро развиваться.
Следует отметить, что повсеместно культивируемый двуспоровый шампиньон в природе встречается довольно редко и его не следует смешивать с шампиньоном обыкновенным, который довольно широко распространен, однако по целому ряду причин менее пригоден к культивированию, чем двуспоровый.
Шампиньоны в каменоломнях под Парижем
Из Франции культура шампиньонов в XVIII в. перешла в Англию, в Германию и другие страны Европы, а также в США. В середине XVIII в. эти грибы начали выращивать и в России. Впервые вопрос о культивировании здесь шампиньонов обсуждался в статье агронома А. Болотова, опубликовавшего в 1778 г. в журнале "Экономический магазин" статью "О шампиньонах", где он делился своим опытом выращивания этих грибов в подвалах. Однако деятельность Болотова носила больше характер любительских поисков. Промышленным выращиванием шампиньонов в России начал заниматься начиная с 1848 г. петербургский огородник Е.А.Грачев. Из провинциальной прессы XIX в. до нас дошли также сведения о том, что еще в 20-х годах прошлого века в небольших количествах выращивал шампиньоны для продажи крестьянин Осинин из Ростовского уезда.
В то время шампиньоны выращивали в подвалах и в специально оборудованных теплицах, или шампиньонницах, похожих на блиндажи, где на полу или на двух-или трехъярусных стеллажах устраивали гряды из специально подготовленного конского навоза. Вначале гряды заражались грибницей, взятой с мест, где шампиньоны росли обильно в естественных условиях. Пересаженная грибница, естественно, была не стерильной, вместе с ней в шампиньонницы заносились вредители и болезни шампиньонов, поэтому урожаи культивируемых шампиньонов были весьма скромными, вполне удовлетворительным считался урожай в 4 кг с 1 м2 гряды. В 1861 г. в окрестностях Петербурга было устроено 10 шампиньонных теплиц, а к 1900 г. их уже насчитывалось около 100.
В отличие от петербургских огородников московские огородники предпочли иной тип шампиньонных теплиц — комбинированные для выгонки шампиньонов и для выгонки зелени и овощей. Дело в том, что в Москве, где влияние французской кухни было значительно слабее, шампиньоны пользовались меньшим спросом, тем более, что природные условия здесь были благоприятны для естественного роста таких первоклассных грибов, как белый, подберезовик и др.
В начале XX в., когда научились уже выращивать стерильную грибницу шампиньона в лабораториях и стали употреблять ее для посадки гряд, урожаи шампиньонов резко повысились и сократились потери от болезней и вредителей. Поскольку эта культура стала приносить стабильные доходы, она стала быстро развиваться.
Следует отметить, что повсеместно культивируемый двуспоровый шампиньон в природе встречается довольно редко и его не следует смешивать с шампиньоном обыкновенным, который довольно широко распространен, однако по целому ряду причин менее пригоден к культивированию, чем двуспоровый.
 Культивация шампионов
Шло время, методы выращивания шампиньонов постепенно совершенствовались, улучшалось качество грибницы, резко возросла механизация всех процессов ее производства, чему безусловно способствовало значительное повышение спроса на грибы на мировом рынке и исключительно благоприятные перспективы на будущее. В настоящее время объем мировой продукции шампиньонов настолько увеличился, что грибоводство выделилось в самостоятельную, очень сложную и технически оснащенную специализированную отрасль сельского хозяйства.
Большой толчок развитию грибоводства дала возникшая проблема нехватки корма для скота (дело в том, что для получения жизненно необходимого людям животного белка нужно скармливать животным огромное количество растительного сырья). Значительный вклад в решение этой проблемы можно было бы внести, используя "кормовые" грибы. Грибы весьма полезны для скота, а также для рыб. Результаты многолетних опытов в нашей стране и за рубежом показали, что грибы являются дополнительным полноценным кормом для скота; причем для этих целей можно применять как плодовые тела, так и субстрат, проросший мицелием. Для скармливания животным пригодны практически все виды шляпочных грибов и многие микроскопические грибы, за исключением ядовитых, которые могут употребляться только свиньями. Вот почему производство грибов для кормовых целей — весьма перспективная отрасль грибоводства.
Сейчас во Франции, в Англии, США, Голландии, ФРГ, а также в некоторых социалистических странах создана целая грибная индустрия, включающая не только выращивание, но и многообразную переработку грибов.
Культивация шампионов
Шло время, методы выращивания шампиньонов постепенно совершенствовались, улучшалось качество грибницы, резко возросла механизация всех процессов ее производства, чему безусловно способствовало значительное повышение спроса на грибы на мировом рынке и исключительно благоприятные перспективы на будущее. В настоящее время объем мировой продукции шампиньонов настолько увеличился, что грибоводство выделилось в самостоятельную, очень сложную и технически оснащенную специализированную отрасль сельского хозяйства.
Большой толчок развитию грибоводства дала возникшая проблема нехватки корма для скота (дело в том, что для получения жизненно необходимого людям животного белка нужно скармливать животным огромное количество растительного сырья). Значительный вклад в решение этой проблемы можно было бы внести, используя "кормовые" грибы. Грибы весьма полезны для скота, а также для рыб. Результаты многолетних опытов в нашей стране и за рубежом показали, что грибы являются дополнительным полноценным кормом для скота; причем для этих целей можно применять как плодовые тела, так и субстрат, проросший мицелием. Для скармливания животным пригодны практически все виды шляпочных грибов и многие микроскопические грибы, за исключением ядовитых, которые могут употребляться только свиньями. Вот почему производство грибов для кормовых целей — весьма перспективная отрасль грибоводства.
Сейчас во Франции, в Англии, США, Голландии, ФРГ, а также в некоторых социалистических странах создана целая грибная индустрия, включающая не только выращивание, но и многообразную переработку грибов.
 Современный шампиньонный цех в совхозе 'Московский'
Старая технология выращивания шампиньонов обеспечивала урожаи от 5 до 9 кг на 1 м2 гряды или стеллажа, причем в год удавалось делать всего два оборота, и, таким образом максимальный годовой урожай с единицы площади составлял 18 кг. По новой технологии выращивания с 1 м2 собирают от 14 до 22 кг грибов, а число оборотов увеличилось до 5 в год. Сейчас в производстве шампиньонов используют четырехъярусные стеллажи, поэтому с 1 м2 полезной площади шампиньонницы получают в год до 400 кг грибов. Следовательно, за 50 лет урожайность шампиньонов увеличилась в 22 раза! У нас в стране шампиньоны выращиваются в пригородных овощных хозяйствах почти всех крупных городов. Под Москвой, Ленинградом, Киевом, Кишиневом, Одессой и Свердловском и вблизи других городов созданы и успешно работают круглый год специализированные цехи по производству грибов. Мощный, современно оборудованный большой цех можно увидеть в совхозе "Московский" неподалеку от столицы. Грибница для них выращивается на специальном заводе, который находится в подмосковном совхозе "Заречье". Этот завод оснащен самым современным оборудованием, он снабжает стерильной грибницей и другие грибоводческие хозяйства, а также грибоводов-любителей.
Современный шампиньонный цех в совхозе 'Московский'
Старая технология выращивания шампиньонов обеспечивала урожаи от 5 до 9 кг на 1 м2 гряды или стеллажа, причем в год удавалось делать всего два оборота, и, таким образом максимальный годовой урожай с единицы площади составлял 18 кг. По новой технологии выращивания с 1 м2 собирают от 14 до 22 кг грибов, а число оборотов увеличилось до 5 в год. Сейчас в производстве шампиньонов используют четырехъярусные стеллажи, поэтому с 1 м2 полезной площади шампиньонницы получают в год до 400 кг грибов. Следовательно, за 50 лет урожайность шампиньонов увеличилась в 22 раза! У нас в стране шампиньоны выращиваются в пригородных овощных хозяйствах почти всех крупных городов. Под Москвой, Ленинградом, Киевом, Кишиневом, Одессой и Свердловском и вблизи других городов созданы и успешно работают круглый год специализированные цехи по производству грибов. Мощный, современно оборудованный большой цех можно увидеть в совхозе "Московский" неподалеку от столицы. Грибница для них выращивается на специальном заводе, который находится в подмосковном совхозе "Заречье". Этот завод оснащен самым современным оборудованием, он снабжает стерильной грибницей и другие грибоводческие хозяйства, а также грибоводов-любителей.
 Современный шампиньонный цех в совхозе 'Московский'
Грибоводы-любители выращивают не только шампиньоны, но и другие съедобные грибы — вешенку обыкновенную и фламмулину бархатистую, или зимний гриб, причем просто в банках.
Современный шампиньонный цех в совхозе 'Московский'
Грибоводы-любители выращивают не только шампиньоны, но и другие съедобные грибы — вешенку обыкновенную и фламмулину бархатистую, или зимний гриб, причем просто в банках.
Вольвариелла
 На таких грядках из рисовой соломы выращивают в странах Юго-Восточной Азии нежный хрупкий гриб — вольвариеллу
Из других почвенных сапротрофов выращивают вольвариеллу съедобную, которую часто называют травяным шампиньоном, хотя она сродни мухоморам и грибу-поплавку, а к шампиньонам никакого отношения не имеет. Надо сказать, что в Японии, Китае, Индонезии, Бирме и Таиланде этот гриб широко культивируют в промышленных масштабах на рисовой соломе, используя в качестве посадочного материала специально приготовленную грибницу. Наиболее благоприятные условия для выращивания вольвариеллы — сочетание температуры воздуха в 28°С и влажности около 80%. Температура в соломенной гряде должна быть 32-42°С, что соответствует тропическим и субтропическим районам, где культура ведется на открытом воздухе, что делает продукцию сравнительно дешевой. В зонах с умеренным климатом вольвариеллу выращивают в закрытом грунте, а поскольку это связано с большими затратами, культивирование ее здесь распространено меньше. Вольвариелла — нежный гриб с серой шляпкой и хрупкой ножкой. Собирают его тогда, когда масса каждого плодового тела достигает 30-50 г. В последнее время положительные результаты дали опыты по выращиванию вольвариеллы на среде из перемолотых початков кукурузы. Опыты проводятся в Венгрии, Голландии и других странах Европы, причем в ряде случаев удалось довести урожай до 160 кг с 1м гряд в год. По данным на 1975 г., всего в мире было выращено 42 тыс. т грибов этого вида.
На таких грядках из рисовой соломы выращивают в странах Юго-Восточной Азии нежный хрупкий гриб — вольвариеллу
Из других почвенных сапротрофов выращивают вольвариеллу съедобную, которую часто называют травяным шампиньоном, хотя она сродни мухоморам и грибу-поплавку, а к шампиньонам никакого отношения не имеет. Надо сказать, что в Японии, Китае, Индонезии, Бирме и Таиланде этот гриб широко культивируют в промышленных масштабах на рисовой соломе, используя в качестве посадочного материала специально приготовленную грибницу. Наиболее благоприятные условия для выращивания вольвариеллы — сочетание температуры воздуха в 28°С и влажности около 80%. Температура в соломенной гряде должна быть 32-42°С, что соответствует тропическим и субтропическим районам, где культура ведется на открытом воздухе, что делает продукцию сравнительно дешевой. В зонах с умеренным климатом вольвариеллу выращивают в закрытом грунте, а поскольку это связано с большими затратами, культивирование ее здесь распространено меньше. Вольвариелла — нежный гриб с серой шляпкой и хрупкой ножкой. Собирают его тогда, когда масса каждого плодового тела достигает 30-50 г. В последнее время положительные результаты дали опыты по выращиванию вольвариеллы на среде из перемолотых початков кукурузы. Опыты проводятся в Венгрии, Голландии и других странах Европы, причем в ряде случаев удалось довести урожай до 160 кг с 1м гряд в год. По данным на 1975 г., всего в мире было выращено 42 тыс. т грибов этого вида.
Кольцевик
 Кольцевик, или строфария морщинисто-кольцевая — новый и неприхотливый культивируемый гриб
Очень ценным и перспективным для выращивания почвенным сапротрофом является строфария кольцевая, или кольцевик, как его называют в отечественной литературе. Это пластинчатый гриб с каштаново-красной шляпкой и серо-голубыми пластинками, диаметр шляпки 8-10 см, иногда достигает 25 см. Масса гриба в среднем 100-150 г. По вкусу кольцевик напоминает подосиновик и в естественных условиях плодоносит с августа по сентябрь, но встречается редко и необильно. Распространен он в Западной и Центральной Европе, Северной и Южной Америке. Кроме питательной ценности и отличных вкусовых качеств, преимущество его в том, что он довольно легко поддается культивированию, причем для выращивания кольцевика используется очень простой субстрат — увлажненная солома без добавления в нее азотных, фосфорных или калийных удобрений, поскольку они отрицательно сказываются на росте грибницы. Попытки обогащения питательной среды после прорастания грибницы или подкормка тоже не дали положительных результатов.
Оптимальные условия для роста кольцевика могут быть созданы в парнике, где нетрудно организовать проветривание и защиту от воздействия солнечных лучей. Парник предохраняет субстрат от дождя и пересушки,, в нем легко поддерживать оптимальную для развития грибницы температуру 28 С. От устройства грядок до сбора первого урожая кольцевика проходит около 4 недель. В отличие от шампиньонов кольцевик собирают уже полностью созревшим, т. е. когда оболочка, прикрывающая его пластинки, прорвана, но шляпка еще имеет колоколообразную форму. Наиболее поздним сроком сбора урожая является момент, когда края шляпок выпрямляются, а пластинки еще имеют серый цвет. Не следует собирать перезрелые плодовые тела с выгнутыми краями шляпки и черными пластинками — такие грибы становятся невкусными.
Проведенные в нашей стране опыты по выращиванию кольцевика показали, что он является довольно плодоносным и дает урожай 16 кг с 1 м2 грядки. Исключительная устойчивость этого гриба к неблагоприятным условиям, особенно к колебанию температуры, позволяет выращивать его не только в закрытых помещениях, но и в открытом грунте, что значительно удешевляет его производство.
Технология выращивания кольцевика была разработана в 1969 г. специалистами ГДР, и сейчас его начали выращивать в Польше, Венгрии и Англии.
Из почвенных сапротрофов перспективными для культивирования являются, по-видимому, гриб-зонтик (пестрый и белый), луговой опенок, рядовка фиолетовая и навозник белый. Пока с этими грибами ведутся лишь экспериментальные исследования, не выходящие за рамки лабораторных, интересуются выращиванием этих грибов и грибоводы-любители.
Кольцевик, или строфария морщинисто-кольцевая — новый и неприхотливый культивируемый гриб
Очень ценным и перспективным для выращивания почвенным сапротрофом является строфария кольцевая, или кольцевик, как его называют в отечественной литературе. Это пластинчатый гриб с каштаново-красной шляпкой и серо-голубыми пластинками, диаметр шляпки 8-10 см, иногда достигает 25 см. Масса гриба в среднем 100-150 г. По вкусу кольцевик напоминает подосиновик и в естественных условиях плодоносит с августа по сентябрь, но встречается редко и необильно. Распространен он в Западной и Центральной Европе, Северной и Южной Америке. Кроме питательной ценности и отличных вкусовых качеств, преимущество его в том, что он довольно легко поддается культивированию, причем для выращивания кольцевика используется очень простой субстрат — увлажненная солома без добавления в нее азотных, фосфорных или калийных удобрений, поскольку они отрицательно сказываются на росте грибницы. Попытки обогащения питательной среды после прорастания грибницы или подкормка тоже не дали положительных результатов.
Оптимальные условия для роста кольцевика могут быть созданы в парнике, где нетрудно организовать проветривание и защиту от воздействия солнечных лучей. Парник предохраняет субстрат от дождя и пересушки,, в нем легко поддерживать оптимальную для развития грибницы температуру 28 С. От устройства грядок до сбора первого урожая кольцевика проходит около 4 недель. В отличие от шампиньонов кольцевик собирают уже полностью созревшим, т. е. когда оболочка, прикрывающая его пластинки, прорвана, но шляпка еще имеет колоколообразную форму. Наиболее поздним сроком сбора урожая является момент, когда края шляпок выпрямляются, а пластинки еще имеют серый цвет. Не следует собирать перезрелые плодовые тела с выгнутыми краями шляпки и черными пластинками — такие грибы становятся невкусными.
Проведенные в нашей стране опыты по выращиванию кольцевика показали, что он является довольно плодоносным и дает урожай 16 кг с 1 м2 грядки. Исключительная устойчивость этого гриба к неблагоприятным условиям, особенно к колебанию температуры, позволяет выращивать его не только в закрытых помещениях, но и в открытом грунте, что значительно удешевляет его производство.
Технология выращивания кольцевика была разработана в 1969 г. специалистами ГДР, и сейчас его начали выращивать в Польше, Венгрии и Англии.
Из почвенных сапротрофов перспективными для культивирования являются, по-видимому, гриб-зонтик (пестрый и белый), луговой опенок, рядовка фиолетовая и навозник белый. Пока с этими грибами ведутся лишь экспериментальные исследования, не выходящие за рамки лабораторных, интересуются выращиванием этих грибов и грибоводы-любители.
Вешенка
 Вешенки — грибы, перспективные для культивирования. В естественных условиях они поселяются на ослабленных деревьях или мертвой древесине
В странах Европы и Северной Америки в последнее десятилетие наибольшее распространение из древесных сапротрофов получила культура вешенки обыкновенной, или устричной. Первые опыты по ее культивированию были проведены в Германии еще до первой мировой войны, а во время войны этот гриб усиленно культивировали как дополнительный источник питания. После войны интерес к культуре вешенки ослаб и лишь с 60-х годов в связи с появлением в Венгрии крупного промышленного производства вешенки обыкновенной на мировом рынке вновь появился спрос на этот гриб.
В последние годы венгерскими учеными разработан интенсивный метод выращивания вешенки в культивационных помещениях в течение всего года на специальном субстрате, для которого используют целлюлозную среду, содержащую стержни початков или стебли кукурузы, солому, опилки, отруби и другие материалы; для обогащения среды в зависимости от рецептуры добавляют солодовые ростки, крахмальную муку, сахарозу и т. д. Среда обычно подвергается пастеризации, после чего из нее готовят блоки, высаживая в нее мицелий, который примерно через 2 недели густо пронизывает среду. После этого температуру понижают и при появлении зачатков плодовых тел обеспечивают достаточное освещение.
Во Франции в научно-исследовательской станции в Бордо успешно исследуется возможность использования для выращивания вешенки коры деревьев и городских отходов. Эти исследования помогут в будущем выращивать на таком субстрате и другие грибы, решая одновременно важнейшую проблему очистки окружающей среды от бытовых загрязнении путем биологического уничтожения промышленных и бытовых отходов.
Шляпка у вешенки обыкновенной от 5 до 30 см в диаметре, более или менее выпуклая, неправильно округлая, языко- или уховидная, гладкая, голая, волокнистая, иногда с беловатым мицелиальным налетом, в начале развития темноокрашенная, позже серая, серо-бурая, серо-коричневая, часто с сизоватым оттенком, в центре выцветающая. Ножка 2-8x2-3 см, эксцентрическая, белая, плотная, в основании часто волнистая. У большинства экземпляров ножка хорошо развита, сравнительно длинная, но встречаются грибы, имеющие боковую, еле заметную ножку, а иногда и без ножки. Мякоть у гриба белая, сочная, мягкая, с возрастом становится немного жестковатой и волокнистой, а в ножке даже пробковидной с запахом отсыревшей муки. В нашей стране вешенка встречается в Арктике, европейской части, на Кавказе, в Сибири, на Дальнем Востоке и в Средней Азии.
Культивируют вешенку обыкновенную в ГДР, Венгрии, США, во Франции, в Италии, Австрии, Голландии и Швейцарии, однако общее производство ее в этих странах не превышает 20 тыс. т в год. В ограниченных количествах вешенка выращивается и в нашей стране.
В Венгриии экспериментально было установлено, что вешенку обыкновенную можно выращивать на ослабленных деревьях путем заражения их ее мицелием. Позже этот метод выращивания был расширен за счет употребления отрезков древесины. Для этого используют заранее срубленные отрезки стволов, которые 1-2 дня вымачивают в воде и после этого заражают мицелием, который через 1-2 мес полностью пронизывает древесину. Приготовленные таким способом отрезки древесины переносят в конце лета на плантацию, располагают на расстоянии 20-25 см друг от друга и закапывают на 1/3 в землю. При такой культуре 1 ц древесины дает в среднем около 20 кг грибов, причем наивысший урожай собирается на третий год выращивания. Довольно часто вешенку выращивают на лесосеках. Дело в том, что корчевание пней на вырубках — дорогая и трудоемкая работа, а при заражении пней грибницей вешенки можно собирать значительный урожай грибов и одновременно за 3-5 лет полностью биологически разрушить пни.
Вешенки — грибы, перспективные для культивирования. В естественных условиях они поселяются на ослабленных деревьях или мертвой древесине
В странах Европы и Северной Америки в последнее десятилетие наибольшее распространение из древесных сапротрофов получила культура вешенки обыкновенной, или устричной. Первые опыты по ее культивированию были проведены в Германии еще до первой мировой войны, а во время войны этот гриб усиленно культивировали как дополнительный источник питания. После войны интерес к культуре вешенки ослаб и лишь с 60-х годов в связи с появлением в Венгрии крупного промышленного производства вешенки обыкновенной на мировом рынке вновь появился спрос на этот гриб.
В последние годы венгерскими учеными разработан интенсивный метод выращивания вешенки в культивационных помещениях в течение всего года на специальном субстрате, для которого используют целлюлозную среду, содержащую стержни початков или стебли кукурузы, солому, опилки, отруби и другие материалы; для обогащения среды в зависимости от рецептуры добавляют солодовые ростки, крахмальную муку, сахарозу и т. д. Среда обычно подвергается пастеризации, после чего из нее готовят блоки, высаживая в нее мицелий, который примерно через 2 недели густо пронизывает среду. После этого температуру понижают и при появлении зачатков плодовых тел обеспечивают достаточное освещение.
Во Франции в научно-исследовательской станции в Бордо успешно исследуется возможность использования для выращивания вешенки коры деревьев и городских отходов. Эти исследования помогут в будущем выращивать на таком субстрате и другие грибы, решая одновременно важнейшую проблему очистки окружающей среды от бытовых загрязнении путем биологического уничтожения промышленных и бытовых отходов.
Шляпка у вешенки обыкновенной от 5 до 30 см в диаметре, более или менее выпуклая, неправильно округлая, языко- или уховидная, гладкая, голая, волокнистая, иногда с беловатым мицелиальным налетом, в начале развития темноокрашенная, позже серая, серо-бурая, серо-коричневая, часто с сизоватым оттенком, в центре выцветающая. Ножка 2-8x2-3 см, эксцентрическая, белая, плотная, в основании часто волнистая. У большинства экземпляров ножка хорошо развита, сравнительно длинная, но встречаются грибы, имеющие боковую, еле заметную ножку, а иногда и без ножки. Мякоть у гриба белая, сочная, мягкая, с возрастом становится немного жестковатой и волокнистой, а в ножке даже пробковидной с запахом отсыревшей муки. В нашей стране вешенка встречается в Арктике, европейской части, на Кавказе, в Сибири, на Дальнем Востоке и в Средней Азии.
Культивируют вешенку обыкновенную в ГДР, Венгрии, США, во Франции, в Италии, Австрии, Голландии и Швейцарии, однако общее производство ее в этих странах не превышает 20 тыс. т в год. В ограниченных количествах вешенка выращивается и в нашей стране.
В Венгриии экспериментально было установлено, что вешенку обыкновенную можно выращивать на ослабленных деревьях путем заражения их ее мицелием. Позже этот метод выращивания был расширен за счет употребления отрезков древесины. Для этого используют заранее срубленные отрезки стволов, которые 1-2 дня вымачивают в воде и после этого заражают мицелием, который через 1-2 мес полностью пронизывает древесину. Приготовленные таким способом отрезки древесины переносят в конце лета на плантацию, располагают на расстоянии 20-25 см друг от друга и закапывают на 1/3 в землю. При такой культуре 1 ц древесины дает в среднем около 20 кг грибов, причем наивысший урожай собирается на третий год выращивания. Довольно часто вешенку выращивают на лесосеках. Дело в том, что корчевание пней на вырубках — дорогая и трудоемкая работа, а при заражении пней грибницей вешенки можно собирать значительный урожай грибов и одновременно за 3-5 лет полностью биологически разрушить пни.
Летний опенок
 Летний опенок
Очень урожаен и неприхотлив к условиям вкусный гриб летний опенок. В ГДР микологи разработали способ его выращивания на древесине. Экспериментальные работы по выращиванию опенка на опилках и других отходах лесной промышленности ведутся и в нашей стране. Для этого гриба характерен довольно быстрый линейный рост вегетативного мицелия в чистой культуре; ежедневный прирост у большинства штаммов этого гриба составлял 5 мм; гриб способен в относительно короткие сроки формировать и плодовые тела.
Для культивирования опенка летнего наиболее пригодна древесина лиственных пород, в первую очередь березы. Свежесрубленная древесина березы содержит достаточное количество влаги, а плотная кора предохраняет ее от преждевременного высыхания. Опенок можно культивировать на древесине непосредственно в лесу, а также в теплицах, подвалах, на огородах.
Очень перспективным и экономически выгодным является выращивание гриба на специально заготовленных чурках длиной 25 см. Проверкой различных способов заражения чурок мицелием с помощью специальной прививочной пасты установлено, что самым надежным является способ внесения прививочной пасты в отверстие на торцовой и боковой поверхности чурок. В этом случае мицелий легко приживается в древесине и начинает быстро распространяться вдоль волокон.
В Японии сконструирован автомат, который просверливает отверстия в древесине, одновременно внося в них мицелий. Такие автоматы применяются при культивировании сиитаке, однако использование их (возможно, с некоторыми конструктивными изменениями) для выращивания опенка летнего не вызывает сомнений.
Формирование плодовых тел летнего опенка начинается примерно через 3-4 мес после заражения древесины мицелием. Товарных размеров грибы достигают спустя 10-15 дней после начала их роста.
Опенок летний — ценный продукт питания: содержит различные органические соединения, минеральные соли и биологически активные вещества. Эти вещества придают грибу характерный аромат и своеобразный, очень приятный вкус. При искусственном культивировании ставится задача получить плодовые тела опенка летнего, не уступающие по пищевой ценности грибам, выросшим в естественных условиях. Производство летнего опенка в Японии в 1975 г. превысило 15 тыс. т в год. Хорошие результаты по выращиванию летнего опенка получены в нашей стране (в Белоруссии).
Летний опенок
Очень урожаен и неприхотлив к условиям вкусный гриб летний опенок. В ГДР микологи разработали способ его выращивания на древесине. Экспериментальные работы по выращиванию опенка на опилках и других отходах лесной промышленности ведутся и в нашей стране. Для этого гриба характерен довольно быстрый линейный рост вегетативного мицелия в чистой культуре; ежедневный прирост у большинства штаммов этого гриба составлял 5 мм; гриб способен в относительно короткие сроки формировать и плодовые тела.
Для культивирования опенка летнего наиболее пригодна древесина лиственных пород, в первую очередь березы. Свежесрубленная древесина березы содержит достаточное количество влаги, а плотная кора предохраняет ее от преждевременного высыхания. Опенок можно культивировать на древесине непосредственно в лесу, а также в теплицах, подвалах, на огородах.
Очень перспективным и экономически выгодным является выращивание гриба на специально заготовленных чурках длиной 25 см. Проверкой различных способов заражения чурок мицелием с помощью специальной прививочной пасты установлено, что самым надежным является способ внесения прививочной пасты в отверстие на торцовой и боковой поверхности чурок. В этом случае мицелий легко приживается в древесине и начинает быстро распространяться вдоль волокон.
В Японии сконструирован автомат, который просверливает отверстия в древесине, одновременно внося в них мицелий. Такие автоматы применяются при культивировании сиитаке, однако использование их (возможно, с некоторыми конструктивными изменениями) для выращивания опенка летнего не вызывает сомнений.
Формирование плодовых тел летнего опенка начинается примерно через 3-4 мес после заражения древесины мицелием. Товарных размеров грибы достигают спустя 10-15 дней после начала их роста.
Опенок летний — ценный продукт питания: содержит различные органические соединения, минеральные соли и биологически активные вещества. Эти вещества придают грибу характерный аромат и своеобразный, очень приятный вкус. При искусственном культивировании ставится задача получить плодовые тела опенка летнего, не уступающие по пищевой ценности грибам, выросшим в естественных условиях. Производство летнего опенка в Японии в 1975 г. превысило 15 тыс. т в год. Хорошие результаты по выращиванию летнего опенка получены в нашей стране (в Белоруссии).
Зимний гриб
 Зимний гриб, или фламмулину бархатистую, выращивают на фермах в Японии в банках и срезают, как цветы
В Японии и на Тайване широко культивируют древоразрушающий гриб — зимний гриб, или фламмулину бархатистую, или зимний опенок. В этих странах, а также в Корее есть даже специализированные фермы, где этот гриб выращивается в стеклянных банках на смеси опилок или соломы с минеральными добавлениями. Появившиеся из горлышка банки плодовые тела на длинных ножках срезают, как цветы, а на их месте через некоторое время вырастает новый "букет". В Голландии проводились опыты по промышленному выращиванию зимнего гриба, причем грибоводы установили, что лучшие результаты получаются при использовании в качестве субстрата для него среды, состоящей из 70% опилок и 30% рисовых отрубей; сбор урожая начинается через 2-3 недели после зарастания субстрата мицелием.
В последнее время очень удачные опыты по выращиванию зимних опенков проведены в ФРГ, где в холодное время года буковые поленья, зараженные грибницей, держали в овощехранилище, а с наступлением тепла перенесли в открытый грунт. Урожай снимали осенью, причем собрали примерно по 150 шт. грибов с полена. Это отличный результат, если учесть, что попадались грибы массой и по 50 г. Следует, однако, отметить, что такие результаты были получены только после того, как исследователи взяли зимний опенок родом из Японии; свои, европейские, опенки таким способом вырастить пока не удалось. Зимний гриб обладает хорошими вкусовыми качествами. Шляпка у него 2-8 см в диаметре, медно-желтая, во влажном состоянии слизистая, а у старых грибов с бурыми пятнами и точками. В естественных условиях этот гриб произрастает на всех континентах, кроме Антарктиды, и появляется поздно осенью, часто после заморозков. Временами, после каждой оттепели, смерзшийся гриб продолжает расти. Перед употреблением в пищу его необходимо хорошо прожарить.
Таким образом, в настоящее время для искусственного выращивания в промышленных масштабах освоено только около 10 видов грибов, хотя попытки одомашнивания были предприняты в отношении 65 видов грибов, относящихся более чем к 24 родам, причем у большинства из них в лабораторных условиях отмечалось плодоношение, что обнадеживает. Имеется еще один важный аспект, который требует несколько иного подхода к поискам новых видов грибов для промышленного культивирования. Это возможность использования этих организмов для фармацевтических целей.
Многочисленные труды, пришедшие к нам из древности, а также многовековой опыт народной медицины, передающийся у некоторых народов из поколения в поколение, свидетельствуют о том, что уже тогда, а особенно в средние века, грибы наряду с высшими растениями применялись как лекарственные средства. Тем не менее в последние десятилетия лечебное действие грибов-макромицетов почти не изучалось. Правда, во многих развивающихся странах, главным образом в отсталых сельских районах, где до сих пор еще очень трудно получить квалифицированную медицинскую помощь, грибы и в настоящее время достаточно широко применяются с лечебной целью, причем в большинстве случаев рецепты по применению грибов для лечения заимствуются из средневековья. Лиственничная губка — очень медленно растущий трутовик, встречающийся в южных районах Европы, в Северной Америке и в европейской части СССР всюду, где произрастают лиственница и кедр, была известна еще древним грекам и римлянам и упоминается в трудах Плиния как отличное слабительное и кровоостанавливающее средство. В средневековых книгах о лекарственных травах сообщалось об успешном применении этого гриба при лечении грудных заболеваний, против ночной потливости больных туберкулезом, против ревматизма, желтухи и водянки. Мы не склонны считать применение лиственничной губки исцеляющим средством от этих болезней, но необходимость серьезного изучения лечебных свойств макромицетов очевидна.
Кстати, в Якутии лиственничную губку в прошлом использовали вместо мыла, а в некоторых местах этот гриб идет на приготовление пива, заменяя хмель. Химики установили, что этот гриб содержит активные смолы и агарициновые кислоты.
Проблема разведения грибов по-прежнему остается весьма актуальной, поскольку она способна решить сразу несколько важных задач: на малых площадях производить значительное количество белковой пищи для людей; без серьезных затрат значительно увеличить количество кормов для скота и искусственно разводимой рыбы; удешевить и упростить утилизацию некоторых промышленных и бытовых отходов; послужить защитой дикорастущим грибам. Поэтому интенсивные исследования в этой области продолжаются; с 1950 г. создана Международная комиссия по грибоводству, которая раз в 3 года проводит международные научные конгрессы по теории и практике производства съедобных грибов.
Разведение съедобных грибов вполне возможно и в домашних условиях на приусадебных и садовых участках. Сейчас для разведения можно рекомендовать шампиньон, но когда у нас будет освоено производство стерильной грибницы вешенки обыкновенной, опенков летнего и зимнего и кольцевика, а такое освоение приближается к успешному завершению, эти виды, несомненно, также привлекут к себе внимание грибоводов-любителей, тем более, что выращивание этих грибов по своей технологии проще и доступнее, чем выращивание шампиньонов.
Зимний гриб, или фламмулину бархатистую, выращивают на фермах в Японии в банках и срезают, как цветы
В Японии и на Тайване широко культивируют древоразрушающий гриб — зимний гриб, или фламмулину бархатистую, или зимний опенок. В этих странах, а также в Корее есть даже специализированные фермы, где этот гриб выращивается в стеклянных банках на смеси опилок или соломы с минеральными добавлениями. Появившиеся из горлышка банки плодовые тела на длинных ножках срезают, как цветы, а на их месте через некоторое время вырастает новый "букет". В Голландии проводились опыты по промышленному выращиванию зимнего гриба, причем грибоводы установили, что лучшие результаты получаются при использовании в качестве субстрата для него среды, состоящей из 70% опилок и 30% рисовых отрубей; сбор урожая начинается через 2-3 недели после зарастания субстрата мицелием.
В последнее время очень удачные опыты по выращиванию зимних опенков проведены в ФРГ, где в холодное время года буковые поленья, зараженные грибницей, держали в овощехранилище, а с наступлением тепла перенесли в открытый грунт. Урожай снимали осенью, причем собрали примерно по 150 шт. грибов с полена. Это отличный результат, если учесть, что попадались грибы массой и по 50 г. Следует, однако, отметить, что такие результаты были получены только после того, как исследователи взяли зимний опенок родом из Японии; свои, европейские, опенки таким способом вырастить пока не удалось. Зимний гриб обладает хорошими вкусовыми качествами. Шляпка у него 2-8 см в диаметре, медно-желтая, во влажном состоянии слизистая, а у старых грибов с бурыми пятнами и точками. В естественных условиях этот гриб произрастает на всех континентах, кроме Антарктиды, и появляется поздно осенью, часто после заморозков. Временами, после каждой оттепели, смерзшийся гриб продолжает расти. Перед употреблением в пищу его необходимо хорошо прожарить.
Таким образом, в настоящее время для искусственного выращивания в промышленных масштабах освоено только около 10 видов грибов, хотя попытки одомашнивания были предприняты в отношении 65 видов грибов, относящихся более чем к 24 родам, причем у большинства из них в лабораторных условиях отмечалось плодоношение, что обнадеживает. Имеется еще один важный аспект, который требует несколько иного подхода к поискам новых видов грибов для промышленного культивирования. Это возможность использования этих организмов для фармацевтических целей.
Многочисленные труды, пришедшие к нам из древности, а также многовековой опыт народной медицины, передающийся у некоторых народов из поколения в поколение, свидетельствуют о том, что уже тогда, а особенно в средние века, грибы наряду с высшими растениями применялись как лекарственные средства. Тем не менее в последние десятилетия лечебное действие грибов-макромицетов почти не изучалось. Правда, во многих развивающихся странах, главным образом в отсталых сельских районах, где до сих пор еще очень трудно получить квалифицированную медицинскую помощь, грибы и в настоящее время достаточно широко применяются с лечебной целью, причем в большинстве случаев рецепты по применению грибов для лечения заимствуются из средневековья. Лиственничная губка — очень медленно растущий трутовик, встречающийся в южных районах Европы, в Северной Америке и в европейской части СССР всюду, где произрастают лиственница и кедр, была известна еще древним грекам и римлянам и упоминается в трудах Плиния как отличное слабительное и кровоостанавливающее средство. В средневековых книгах о лекарственных травах сообщалось об успешном применении этого гриба при лечении грудных заболеваний, против ночной потливости больных туберкулезом, против ревматизма, желтухи и водянки. Мы не склонны считать применение лиственничной губки исцеляющим средством от этих болезней, но необходимость серьезного изучения лечебных свойств макромицетов очевидна.
Кстати, в Якутии лиственничную губку в прошлом использовали вместо мыла, а в некоторых местах этот гриб идет на приготовление пива, заменяя хмель. Химики установили, что этот гриб содержит активные смолы и агарициновые кислоты.
Проблема разведения грибов по-прежнему остается весьма актуальной, поскольку она способна решить сразу несколько важных задач: на малых площадях производить значительное количество белковой пищи для людей; без серьезных затрат значительно увеличить количество кормов для скота и искусственно разводимой рыбы; удешевить и упростить утилизацию некоторых промышленных и бытовых отходов; послужить защитой дикорастущим грибам. Поэтому интенсивные исследования в этой области продолжаются; с 1950 г. создана Международная комиссия по грибоводству, которая раз в 3 года проводит международные научные конгрессы по теории и практике производства съедобных грибов.
Разведение съедобных грибов вполне возможно и в домашних условиях на приусадебных и садовых участках. Сейчас для разведения можно рекомендовать шампиньон, но когда у нас будет освоено производство стерильной грибницы вешенки обыкновенной, опенков летнего и зимнего и кольцевика, а такое освоение приближается к успешному завершению, эти виды, несомненно, также привлекут к себе внимание грибоводов-любителей, тем более, что выращивание этих грибов по своей технологии проще и доступнее, чем выращивание шампиньонов.
 Вешенка устричная, выращенная на отрезках древесины в теплице
Исключительное многообразие грибов и субстратов, на которых они могут расти, их большая приспособляемость к различным условиям вселяют надежду, что в будущем еще многие их виды смогут быть превращены людьми в огородную культуру. Однако для выявления таких видов, для выработки технологии их искусственного выращивания необходимы многочисленные и терпеливые эксперименты, в проведении которых большую помощь ученым могут оказать грибоводы-любители. Перспективны для искусственного выращивания в первую очередь степной белый гриб, луговые опенки, грибы-зонтики и многие другие виды почвенных и подстилочных сапротрофов. Что касается наиболее ценного гриба — белого, то в России с давних пор пытались выращивать его в лесах, разбрасывая кусочки плодового тела, поливая почву водой, в которой содержатся споры, или перенося почву с грибных участков леса на те, где он не растет. Впервые о таких экспериментах сообщил в литературе А. Т. Болотов (1780 г.), а затем, почти столетие спустя, Никитин (1878 г.). Нечто вроде сводки об этих попытках опубликовал в 1907 г. П. И. Каменоградский, однако никаких практически ценных или научных результатов такие опыты не дали. В 1965 г. польский миколог Карпинский опубликовал отчет об экспериментах по выращиванию белого гриба в лабораторных условиях на искусственной среде. Как видно из отчета, Карпинский получил плодовые тела размером 1 X 1,3 см, однако практического выхода эти эксперименты не получили.
Нам представляется, что искусственное разведение микоризных грибов на существующем уровне знаний об этом явлении маловероятно и практически может быть осуществимо, по-видимому, лишь на новом этапе изучения микологами микоризы — этого очень сложного природного явления.
Вешенка устричная, выращенная на отрезках древесины в теплице
Исключительное многообразие грибов и субстратов, на которых они могут расти, их большая приспособляемость к различным условиям вселяют надежду, что в будущем еще многие их виды смогут быть превращены людьми в огородную культуру. Однако для выявления таких видов, для выработки технологии их искусственного выращивания необходимы многочисленные и терпеливые эксперименты, в проведении которых большую помощь ученым могут оказать грибоводы-любители. Перспективны для искусственного выращивания в первую очередь степной белый гриб, луговые опенки, грибы-зонтики и многие другие виды почвенных и подстилочных сапротрофов. Что касается наиболее ценного гриба — белого, то в России с давних пор пытались выращивать его в лесах, разбрасывая кусочки плодового тела, поливая почву водой, в которой содержатся споры, или перенося почву с грибных участков леса на те, где он не растет. Впервые о таких экспериментах сообщил в литературе А. Т. Болотов (1780 г.), а затем, почти столетие спустя, Никитин (1878 г.). Нечто вроде сводки об этих попытках опубликовал в 1907 г. П. И. Каменоградский, однако никаких практически ценных или научных результатов такие опыты не дали. В 1965 г. польский миколог Карпинский опубликовал отчет об экспериментах по выращиванию белого гриба в лабораторных условиях на искусственной среде. Как видно из отчета, Карпинский получил плодовые тела размером 1 X 1,3 см, однако практического выхода эти эксперименты не получили.
Нам представляется, что искусственное разведение микоризных грибов на существующем уровне знаний об этом явлении маловероятно и практически может быть осуществимо, по-видимому, лишь на новом этапе изучения микологами микоризы — этого очень сложного природного явления.
Рациональное использование и охрана грибных ресурсов
 Наши грибные ресурсы еще велики и надолго останутся такими при бережном к ним отношении
Если заглянуть в недалекое будущее, то уже в следующем десятилетии, по мнению многих ученых, растительные белковые продукты, в число которых, конечно, будут включены и съедобные грибы, сыграют важную роль в существенном увеличении ресурсов белка.
Как уже отмечалось, макроскопические грибы заселяют все континенты земного шара, кроме Антарктиды; причем наряду с ядовитыми и несъедобными везде растут и съедобные грибы, и, таким образом, при заинтересованности населения в их сборе и полезном использовании они везде могли бы быть серьезным подспорьем в питании. Тем не менее в силу различных причин, в том числе и в связи с вековыми национальными традициями, к грибам как к продуктам питания у разных народов сложилось неодинаковое отношение. Любят собирать и широко используют дикорастущие грибы в пищу в Скандинавских странах, в странах Восточной и Центральной Европы, особенно в Румынии, Чехословакии, Польше, Австрии и Швейцарии, в Канаде, на севере США. Почти не собирают дикорастущие грибы в Англии, во Франции, в Италии, африканских странах, Южной Америке, Японии, странах Юго-Западной Азии. Не исключается, конечно, сбор грибов в этих странах отдельными любителями или в отдельных местностях, но в национальные традиционные блюда грибы, как правило, не входят, что, однако, не исключает употребления там в пищу культивируемых грибов. И все же нужно сказать, что такого любовного отношения к сбору и использованию дикорастущих грибов, какое имеет место в нашей стране, где "тихая охота" издавна стала национальной традицией, не наблюдается ни в одной стране мира. Поэтому нам понятен не только растущий интерес к искусственному разведению грибов, но и к резкому увеличению заготовок дикорастущих видов, по запасам которых наша страна не знает себе равных в мире.
Наши грибные ресурсы еще велики и надолго останутся такими при бережном к ним отношении
Если заглянуть в недалекое будущее, то уже в следующем десятилетии, по мнению многих ученых, растительные белковые продукты, в число которых, конечно, будут включены и съедобные грибы, сыграют важную роль в существенном увеличении ресурсов белка.
Как уже отмечалось, макроскопические грибы заселяют все континенты земного шара, кроме Антарктиды; причем наряду с ядовитыми и несъедобными везде растут и съедобные грибы, и, таким образом, при заинтересованности населения в их сборе и полезном использовании они везде могли бы быть серьезным подспорьем в питании. Тем не менее в силу различных причин, в том числе и в связи с вековыми национальными традициями, к грибам как к продуктам питания у разных народов сложилось неодинаковое отношение. Любят собирать и широко используют дикорастущие грибы в пищу в Скандинавских странах, в странах Восточной и Центральной Европы, особенно в Румынии, Чехословакии, Польше, Австрии и Швейцарии, в Канаде, на севере США. Почти не собирают дикорастущие грибы в Англии, во Франции, в Италии, африканских странах, Южной Америке, Японии, странах Юго-Западной Азии. Не исключается, конечно, сбор грибов в этих странах отдельными любителями или в отдельных местностях, но в национальные традиционные блюда грибы, как правило, не входят, что, однако, не исключает употребления там в пищу культивируемых грибов. И все же нужно сказать, что такого любовного отношения к сбору и использованию дикорастущих грибов, какое имеет место в нашей стране, где "тихая охота" издавна стала национальной традицией, не наблюдается ни в одной стране мира. Поэтому нам понятен не только растущий интерес к искусственному разведению грибов, но и к резкому увеличению заготовок дикорастущих видов, по запасам которых наша страна не знает себе равных в мире.
Грибные богатства нашей страны
Определение объема урожаев дикорастущих грибов — задача сложная и не только из-за объема необходимых исследований для сколько-нибудь реального вычисления площадей грибных месторождений, но из-за того, что грибы родятся не ежегодно, да и в течение года они появляются лишь на сравнительно короткий срок. В остальное же время о произрастании их в том или ином месте нельзя и догадаться, поскольку на поверхности земли не остается никаких следов их присутствия. Нельзя об этом судить и по подземной грибнице, поскольку у большинства грибов она морфологически настолько однообразна, что определить по ней виды обычно не удается. Сложность учета наших грибных богатств состоит еще и в том, что участки грибных месторождений чаще разрознены и самой неожиданной конфигурации, что сильно затрудняет работу по составлению карт грибных месторождений. По приблизительным данным, в наших лесах, занимающих площадь более 7 млн. км2, ежегодно плодоносит такое количество съедобных грибов, что если за сезон собрать и рационально использовать хотя бы 5% урожая, мы наводнили бы превосходными грибами все рынки мира. Правда, некоторые специалисты менее оптимистично оценивают наши грибные запасы, определяя их в 3-5 млн. т в сезон, но это тоже весьма внушительная цифра. По данным Б. П. Василькова (Методы учета съедобных грибов в лесах СССР. Л., 1968. 67 с), на 1 человека приходится в среднем в РСФСР (в пределах европейской части и Урала) по 7,9 кг грибов в год, в Белоруссии 4, республиках Прибалтики около 5 и на Украине 1 кг. Правда, данные эти тридцатилетней давности и поэтому нуждаются в уточнении. Для рационального использования грибных запасов, которыми располагают наши леса, необходимы точные сведения о том, в каких типах леса, какого возраста, при каких условиях и в какое время происходит наиболее массовое плодоношение грибов и каких именно видов. Только получив ответы на эти вопросы, можно эффективно использовать наши грибные богатства. Грибы в нашей стране растут не только в лесу, но и в лесотундре, тундре. На севере Урала в изобилии встречаются самые разнообразные грибы, главными потребителями которых являются здесь олени. Обследованиями установлено наличие больших запасов грибов на Чукотке и севере Камчатки, где произрастают низкорослые березы (тощая, каменная, кустарниковая) и ивы, а также кустарниковая форма ольхи. Грибы здесь отличаются большим разнообразием, однако в этих районах их, к сожалению, не собирают. Грибы в изобилии произрастают в обширных лесных массивах, покрывающих горные хребты Кавказа, Крыма, Средней Азии. В горных лесных заповедниках Крыма на высоте около 1000 м над ур. м. встречаются самые разнообразные и часто очень крупные грибы. Но и здесь сбор их практически не ведется, грибные богатства пропадают зря. Съедобные грибы есть даже в Заполярье, на Новой Земле, о. Врангеля и Командорских о-вах; много грибов в полярной лесотундре. Научной методики учета запасов дикорастущих грибов до последнего времени не существовало ни у нас, ни за рубежом, причем нигде, кроме Финляндии, не делалось даже каких-либо попыток провести исследования в этом направлении. В 1930- 1932 гг. советский миколог Б. П. Васильков впервые попытался произвести учет запасов дикорастущих наиболее ценных грибов в двух районах Марийской АССР, а в 50-е годы произвел повторный учет. Однако сейчас методы, используемые им, требуют усовершенствования в соответствии с достижениями математической статистики и возможностями, которые дает нам современная вычислительная техника. В лесах растет основная масса грибов, поэтому охрана грибов это в первую очередь охрана леса
В настоящее время мы еще не располагаем достаточными конкретными сведениями об урожайности грибов, их распределении в лесах различных географических зон СССР, не имеем карт основных месторождений и запасов съедобных грибов, хотя именно эти исследования необходимы для научно обоснованного освоения грибных богатств. Правда, сейчас исследования такого рода проводятся в ряде учреждений и институтах, связанных с лесным хозяйством и лесной промышленностью, а также в некоторых республиканских институтах ботаники. В последнее время сделана серьезная попытка изучить запасы съедобных грибов в сибирских лесах.
В лесах растет основная масса грибов, поэтому охрана грибов это в первую очередь охрана леса
В настоящее время мы еще не располагаем достаточными конкретными сведениями об урожайности грибов, их распределении в лесах различных географических зон СССР, не имеем карт основных месторождений и запасов съедобных грибов, хотя именно эти исследования необходимы для научно обоснованного освоения грибных богатств. Правда, сейчас исследования такого рода проводятся в ряде учреждений и институтах, связанных с лесным хозяйством и лесной промышленностью, а также в некоторых республиканских институтах ботаники. В последнее время сделана серьезная попытка изучить запасы съедобных грибов в сибирских лесах.
Рациональное использование грибных ресурсов
С 1971 г. ученые-микологи проводят чрезвычайно полезную работу по составлению картосхем наиболее урожайных грибных площадей во многих областях нашей страны, которая, однако, осложняется рядом особенностей, связанных с биологией и произрастанием грибов. Мы знаем, например, к какому типу леса приурочен тот или иной вид гриба, но хотя связь гриба с деревьями в природе существует, она не является абсолютной. Видимо, нам неизвестны еще некоторые дополнительные факторы, которые необходимы, чтобы в данном типе леса обязательно вырос определенный гриб. По-видимому, грибы вообще значительно больше, чем другие растения, склонны держать в секрете не только условия своего развития и места произрастания, но и характер своих привязанностей к высшим растениям. Тем не менее основные места массовых заготовок грибов в в принципе уже определены — это лесные массивы центральной и северной полосы европейской части СССР, Сибири и Приморья. Обильно произрастают грибы и в районах Крайнего Севера, но здесь их заготовки затруднены из-за недостатка дорог, отдаленности населенных пунктов и кратковременности грибного сезона. Наиболее урожайными на съедобные шляпочные грибы считаются, по приблизительным данным для Новгородской области, молодые и средневозрастные смешанные леса (урожаи 276,8 кг/га), молодые и средневозрастные сосняки (257,1) и еловые высокоствольные леса (256 кг/га); наименее урожайными считаются старые сомкнутые, глухие леса; средняя урожайность для съедобных грибов по лесам СССР принята 50 кг/га (О. С. Русаков. Материалы по изучению урожайности хозяйственно важных шляпочных грибов. — Микология и фитопатология, 1968, № 1, с. 11-18). При подсчетах урожайности грибов приходится учитывать, что в одном и том же типе леса часто бывают участки, где определенный гриб встречается в больших количествах, и участки, где он крайне редок. Это может зависеть от многих причин — рельефа местности, возраста древесной породы, сомкнутости крон деревьев, микроклимата данного участка (освещенности, влажности, температуры), соседства других грибов. Интересные многолетние наблюдения сделаны по этому поводу великолепным натуралистом-писателем С. Т. Аксаковым, который писал: "Всем охотникам известно, что у грибов есть "любимые места", на которых они непрерывно каждый год родятся в большем или меньшем изобилии... Место-положение, почва, порода деревьев (в парке) — все одинаково, а между тем вот уже 12 лет, как я сам постоянно наблюдаю и каждый год вновь убеждаюсь, что грибы родятся у меня на одних и тех же любимых своих местах, под одними и теми же елями". Речь в этом отрывке идет о рыжиках. Здесь интересно отметить и то обстоятельство, что наблюдения велись долго, 12 лет. Отсюда можно сделать вывод, что при благоприятных условиях некоторые грибы могут плодоносить на одних и тех же местах, вероятно, не один десяток лет. Это очень важно для решения вопроса о том, на какие сроки целесообразно составлять карты грибоносных лесных площадей. Примерная схема месторождения съедобных грибов (номерами обозначены кварталы лесных угодий)
Об обилии плодоношения грибов можно судить по нескольким примерам. В Карелии в июне 1974 г. на одном небольшом участке на скалистом берегу реки, поросшем мелким березняком, за день было собрано 300 кг маслят, которые покрывали весь склон скалы, выглядывали изо всех щелей, из-под камней, мха, образуя сплошной коричневый ковер! Однако в последующие годы в этом месте такого их изобилия уже не наблюдали. В августе 1970 г. по берегам р. Умальты, которая протекает севернее Хабаровска, среди высокоствольного леса из лиственниц и берез на поросшей мхом почве поражало взор необыкновенное изобилие подосиновиков. Они усыпали буквально каждую пядь земли — берега, опушки, тенистые уголки, подножия деревьев и поляны, причем на много километров! Местами грибов было так много, что от их желтовато-оранжевых шляпок, часто величиной с тарелку, просто рябило в глазах. Наиболее крупные из них весили около 1 кг, диаметр шляпки достигал 31 см, а высота ножки до 25 см. Это грибное Эльдорадо Умальты известно местным жителям, геологам, туристам. Пожалуй, нигде больше в Приморье не было такого обилия крупных грибов, однако такое здесь бывает не часто, а лишь в отдельные годы.
Примерная схема месторождения съедобных грибов (номерами обозначены кварталы лесных угодий)
Об обилии плодоношения грибов можно судить по нескольким примерам. В Карелии в июне 1974 г. на одном небольшом участке на скалистом берегу реки, поросшем мелким березняком, за день было собрано 300 кг маслят, которые покрывали весь склон скалы, выглядывали изо всех щелей, из-под камней, мха, образуя сплошной коричневый ковер! Однако в последующие годы в этом месте такого их изобилия уже не наблюдали. В августе 1970 г. по берегам р. Умальты, которая протекает севернее Хабаровска, среди высокоствольного леса из лиственниц и берез на поросшей мхом почве поражало взор необыкновенное изобилие подосиновиков. Они усыпали буквально каждую пядь земли — берега, опушки, тенистые уголки, подножия деревьев и поляны, причем на много километров! Местами грибов было так много, что от их желтовато-оранжевых шляпок, часто величиной с тарелку, просто рябило в глазах. Наиболее крупные из них весили около 1 кг, диаметр шляпки достигал 31 см, а высота ножки до 25 см. Это грибное Эльдорадо Умальты известно местным жителям, геологам, туристам. Пожалуй, нигде больше в Приморье не было такого обилия крупных грибов, однако такое здесь бывает не часто, а лишь в отдельные годы.
 'Тихая охота' издавна стала в нашей стране национальной традицией
Сбор и заготовка грибов в нашей стране производятся начиная с 1931 г. государственными и кооперативными заготовительными организациями — лесхозами и лесничествами Министерства лесного хозяйства РСФСР, организациями Центросоюза, причем переработка грибов организуется на месте сбора, так как они не подлежат транспортировке. Для этого строят сезонные или постоянные грибоприемочные пункты с сушилками и грибоварочным отделением для засолки грибов. Готовятся специальные кадры приемщиков, хорошо знающих грибы, и мастеров-грибоваров, владеющих секретами засолки. Готовая продукция в виде сушеных грибов, расфасованных в банки соленых груздей, рыжиков или маринованных маслят поступает в государственные или кооперативные магазины.
'Тихая охота' издавна стала в нашей стране национальной традицией
Сбор и заготовка грибов в нашей стране производятся начиная с 1931 г. государственными и кооперативными заготовительными организациями — лесхозами и лесничествами Министерства лесного хозяйства РСФСР, организациями Центросоюза, причем переработка грибов организуется на месте сбора, так как они не подлежат транспортировке. Для этого строят сезонные или постоянные грибоприемочные пункты с сушилками и грибоварочным отделением для засолки грибов. Готовятся специальные кадры приемщиков, хорошо знающих грибы, и мастеров-грибоваров, владеющих секретами засолки. Готовая продукция в виде сушеных грибов, расфасованных в банки соленых груздей, рыжиков или маринованных маслят поступает в государственные или кооперативные магазины.
 'Тихая охота' издавна стала в нашей стране национальной традицией
Во избежание отравлений и с учетом невозможности санитарного контроля в нашей стране категорически запрещено торговать на рынках маринованными или солеными грибами.
'Тихая охота' издавна стала в нашей стране национальной традицией
Во избежание отравлений и с учетом невозможности санитарного контроля в нашей стране категорически запрещено торговать на рынках маринованными или солеными грибами.
Правила организации заготовок грибов
В 1981 г. Министерство здравоохранения СССР выпустило санитарные правила по заготовке, переработке и продаже грибов. В соответствии с ними постоянные или временные пункты по заготовке и переработке грибов, а также передвижные механизированные грибоварочные установки должны располагаться на возвышенных, обеспечивающих хороший сток дождевых вод местах и вблизи источников водоснабжения. Нельзя располагать эти пункты вблизи животноводческих ферм, пылящих дорог и других объектов возможного загрязнения зоны пункта. Выбор участков, источников водоснабжения и порядок сброса сточных вод с грибоперерабатывающих пунктов согласовывается с местными органами государственного санитарного надзора. Правилами предусмотрено, что лица; поступающие на работу и работающие на грибоварочных пунктах, подвергаются обязательным медицинским обследованиям и профилактическим прививкам в порядке, установленном органами здравоохранения. Эти лица обязаны пройти общую гигиеническую подготовку, а также специальную подготовку, обеспечивающую надлежащую квалификацию по технологии и гигиеническим требованиям к переработке грибов. Значительная часть грибов собирается грибниками-любителями, для которых сбор грибов -. увлекательное занятие, связанное с познанием родной природы, тесным общением с ней. "Охота брать грибы", как ее называют, такое же увлечение, как охота с ружьем, ужение рыбы или "охота" с фотоаппаратом, позволяющая подсмотреть и запечатлеть много неизвестных нам страниц из жизни природы. Сколько удовольствия доставляет неторопливая прогулка по лесу. А какое сильное волнение вызывает найденный наконец красавец боровик или яркий подосиновик. Не отрицая поэтичности "тихой охоты", следует, однако, констатировать, что значение квалифицированного массового сбора съедобных грибов грибниками-любителями для переработки собственными силами для личного потребления и для сдачи на заготовительные пункты приобретает все большее значение и должно всячески поощряться.Методы и особенности охраны грибов, правила сбора
Грибы — щедрый дар наших лесов, как назвал их известный советский натуралист-фенолог Дмитрий Зуев, посвятив им большую часть своей поэтической книги "Дары русского леса". Но этим даром надо умело пользоваться, быть рачительным хозяином, чтобы не оскудели наши леса. Грибы, как и все другие растения и животные, нуждаются в охране и защите человека. Возьмем, к примеру, пригородные леса, особенно вокруг больших городов. Многолетними наблюдениями и специальными исследованиями установлено, что количество грибов в них значительно уменьшается. Это происходит, во-первых, за счет уплотнения почвы от вытаптывания и, во-вторых, от нарушения лесной подстилки игрибницы при чрезвычайно интенсивном сборе грибов. Дело в том, что при массовом сборе резко сокращается возобновление грибов за счет новых грибниц, вырастающих из спор, так как, унося с собой грибы, мы уносим из леса их споровое, самое жизнеспособное потомство. Вот почему сейчас весьма актуален вопрос об охране грибов в наиболее посещаемых пригородных лесах, вокруг наиболее крупных туристических баз и в районах наиболее оживленных туристических маршрутов. В сентябре 1978 г. на седьмом конгрессе европейских микологов стоял вопрос о разработке мер и правил по охране грибов. В результате многолетних исследований было установлено, что в ряде стран Центральной и Западной Европы, грибные запасы которых не очень велики, некоторые виды грибов находятся на грани исчезновения. Одной из важнейших причин этого является не столько интенсивный сбор их, а бездумное воздействие человека на места обитания грибов — сплошная вырубка лесов, распахивание лугов, целинных степей и т. д. Поэтому в ряде стран специалисты в качестве первого этапа по охране приступили к выявлению редких и исчезающих видов грибов и к составлению "Красных списков грибов", нуждающихся в первоочередной охране. В ФРГ вышло четвертое издание такого списка, работают над составлением списка специалисты ГДР. Конечно, в нашей богатой запасами грибов стране ставить вопрос об их охране в целом пока нет необходимости. Однако вопрос об охране отдельных видов грибов неоднократно обсуждался советскими микологами начиная с середины 70-х годов. Результатом таких обсуждений явилось выявление редких и исчезающих видов грибов в отдельных районах нашей страны и включение некоторых грибов в так называемые региональные красные книги. В "Красную книгу Казахской ССР" (1981 г.) вошло 10 видов грибов, подлежащих охране на территории Казахстана, а в "Красную книгу Латвийской ССР" — 30 видов грибов для охраны на территории Латвии. Например, в "Красную книгу Казахской ССР" вошел шампиньон таблитчатый. Этот гриб очень редок. Его изредка можно найти, кроме Казахстана, в Средней Азии, на Украине, в Сибири, в Арктике (восточно-азиатской тундре). Кроме нашей страны, он найден только в Северной Америке. Растет шампиньон таблитчатый чаще в степях или полупустынях, на глинисто-щебенистых почвах, по склонам низкогорий, приспособился к суровым условиям обитания. Вероятно, поэтому его можно найти и в тундре и даже на о. Врангеля. Как пищевой продукт шампиньон таблитчатый особой ценности не представляет, а вот для селекции культивируемых шампиньонов, которые плохо переносят жару, он весьма перспективен, так как приспособился к жизни в пустыне. Может быть именно от него и пойдет новая линия культивируемых шампиньонов, которые легко можно будет выращивать в Средней Азии, Казахстане и других южных районах нашей страны, где высокие температуры препятствуют развитию шампиньоноводства. В настоящее время 20 видов грибов включены в "Красную книгу СССР". Почему в нашей стране встал вопрос об охране грибов? Неужели 20 их видов находятся под угрозой исчезновения и как вообще можно охранять грибы? Грибы, занесенные в 'Красную книгу СССР': 1 — трутовик зонтичный, или разветвленный; 2 — цезарский гриб; 3 — цветохвостник веретеновидный, или яванский; 4 — рогатик, или клавариадельфус пестиковый; 5 — решеточник, или клатрус красный; 6 — спарассис курчавый, или грибная капуста
Как видно из материала Красной книги, грибы необходимы и природе в целом и человеку в частности. Во-первых, грибы и крупные (макромицеты) и микроскопические (микромицеты)- непременный компонент любого растительного сообщества, будь то лес, луг, поле, болото и т. д. Здесь их основная и наиважнейшая роль — разложение накопленных зелеными растениями органических веществ (опада, лесной подстилки, валежа). Без такой деятельности грибов не может существовать ни одно растительное сообщество, так как в нем прервется цепочка превращения веществ и приостановится их круговорот. Во-вторых, большинство древесных пород, да и многие травянистые растения и кустарники не могут полноценно развиваться без участия грибов (явление микоризы или микотрофии растений).
Грибы, занесенные в 'Красную книгу СССР': 1 — трутовик зонтичный, или разветвленный; 2 — цезарский гриб; 3 — цветохвостник веретеновидный, или яванский; 4 — рогатик, или клавариадельфус пестиковый; 5 — решеточник, или клатрус красный; 6 — спарассис курчавый, или грибная капуста
Как видно из материала Красной книги, грибы необходимы и природе в целом и человеку в частности. Во-первых, грибы и крупные (макромицеты) и микроскопические (микромицеты)- непременный компонент любого растительного сообщества, будь то лес, луг, поле, болото и т. д. Здесь их основная и наиважнейшая роль — разложение накопленных зелеными растениями органических веществ (опада, лесной подстилки, валежа). Без такой деятельности грибов не может существовать ни одно растительное сообщество, так как в нем прервется цепочка превращения веществ и приостановится их круговорот. Во-вторых, большинство древесных пород, да и многие травянистые растения и кустарники не могут полноценно развиваться без участия грибов (явление микоризы или микотрофии растений).
 Еще два гриба из 'Красной книги СССР': ежевик коралловидный и грифола курчавая(трутовик листоватый), или гриб-баран
Еще два гриба из 'Красной книги СССР': ежевик коралловидный и грифола курчавая(трутовик листоватый), или гриб-баран
 Еще два гриба из 'Красной книги СССР': ежевик коралловидный и грифола курчавая(трутовик листоватый), или гриб-баран
В то же время и в хозяйственной деятельности человека грибы играют значительную роль. Дикорастущие грибы — один из важных ресурсов питания, и в ряде мест нашей страны они используются очень интенсивно, что сказывается на их обилии, и поэтому заготовки грибов также нуждаются в определенном регулировании, как и заготовки лекарственных растений. Отсюда становится очевидным, что к охране грибов нужно относиться столь же внимательно, как к охране растений и животных.
Итак, 20 видов грибов подлежат охране по всей территории СССР. Что это за грибы и как их отбирали для помещения в Красную книгу?
Прежде всего это очень редкие виды грибов, находящиеся под угрозой полного исчезновения, такие, например, как феллориния шишковатая. Грибы этой группы встречаются только в каком-либо одном районе нашей страны. У нас этот гриб встречается только в Казахстане и то очень редко. Начиная с 1857 г., когда была сделана первая находка, этот гриб встретился всего 6 раз. Причем вторую находку (1942 г.) отделяют от первой 85 лет. Растет феллориния в пустынях и полупустынях, на песчаных почвах, такырах и солончаках. Столь же редко, как в нашей стране, этот гриб встречается в Южной Австралии, Индии, Африке и Южной Америке. Феллориния шишковатая, по мнению некоторых микологов, очень древний гриб, реликт мелового периода мезозойской эры, т. е., вероятно, появился он около 130 млн. лет назад.
Еще один редкий гриб, нуждающийся в защите человека, решеточник красный. Встречается он у нас изредка в оранжереях в кадках с тропическими растениями, где и был обнаружен в 1947 г. в Ленинграде, а в 1950 г. в Горно-Алтайске. В естественных условиях на территории СССР впервые был найден в Клинском р-не Московской обл. В настоящее время чаще всего встречаются на Кавказе и в Крыму, причем в основном на территории ботанических садов (Сухумского, Никитского). Кроме того, он отмечен во многих странах Европы, в южных областях Северной Америки и в Северной Африке. Но везде рассматривается как заносный вид. Вообще это тропический и субтропический гриб. Его родина — тропические леса и, возможно, субтропики Средиземноморья. Вероятнее всего, на территорию нашей страны он был завезен с тропическими растениями в виде спор или грибницы, а затем акклиматизировался и стал распространяться. Распространение решеточника красного сдерживается, однако, температурным фактором. Изучая распространение этого гриба в европейских странах, мы обнаружили, что он был отнесен к числу редких грибов еще Карлом Клузиусом — известным натуралистом конца XVI — начала XVII вв. Интересно, что рисунок Клузиуса (он его сделал 380 лет назад) настолько точен, что позволяет безошибочно определить этот гриб.
Мы подробно остановились на двух видах редких грибов, но их в списке значительно больше. Однако не весь список состоит из редких видов. Нуждаются в охране отнюдь не вымирающие виды, но такие, которым грозит исчезновение из-за того, что они имеют очень декоративное плодовое тело, привлекающее внимание, как и многие цветы. К таким видам, занесенным в "Красную книгу СССР", относятся ежевик коралловидный, грибы-бараны, или трутовики (грифола) разветвленный, или зонтичный, и листоватый, спарассис курчавый, или грибная капуста, диктиофора, или "дама с вуалью", мутинус собачий, цезарский гриб, сморчок степной и некоторые другие. Чтобы сохранить эти грибы, не следует их срывать, ведь каждый такой гриб даст сотни тысяч спор, которые гарантируют сохранность вида в целом.
Какие же меры по охране редких видов грибов предусматривает "Красная книга СССР"? Прежде всего — привлечь всеобщее внимание к охраняемым организмам. Здесь нужна большая просветительская работа. Хороший опыт в этом отношении имеют микологи Латвийской ССР. В широко распространенном в республике научно-популярном журнале из месяца в месяц печатаются короткие заметки об охраняемых на территории республики грибах, сопровождающиеся иллюстрациями, и, таким образом, население республики знакомится с темп грибами, которые надо беречь.
Еще два гриба из 'Красной книги СССР': ежевик коралловидный и грифола курчавая(трутовик листоватый), или гриб-баран
В то же время и в хозяйственной деятельности человека грибы играют значительную роль. Дикорастущие грибы — один из важных ресурсов питания, и в ряде мест нашей страны они используются очень интенсивно, что сказывается на их обилии, и поэтому заготовки грибов также нуждаются в определенном регулировании, как и заготовки лекарственных растений. Отсюда становится очевидным, что к охране грибов нужно относиться столь же внимательно, как к охране растений и животных.
Итак, 20 видов грибов подлежат охране по всей территории СССР. Что это за грибы и как их отбирали для помещения в Красную книгу?
Прежде всего это очень редкие виды грибов, находящиеся под угрозой полного исчезновения, такие, например, как феллориния шишковатая. Грибы этой группы встречаются только в каком-либо одном районе нашей страны. У нас этот гриб встречается только в Казахстане и то очень редко. Начиная с 1857 г., когда была сделана первая находка, этот гриб встретился всего 6 раз. Причем вторую находку (1942 г.) отделяют от первой 85 лет. Растет феллориния в пустынях и полупустынях, на песчаных почвах, такырах и солончаках. Столь же редко, как в нашей стране, этот гриб встречается в Южной Австралии, Индии, Африке и Южной Америке. Феллориния шишковатая, по мнению некоторых микологов, очень древний гриб, реликт мелового периода мезозойской эры, т. е., вероятно, появился он около 130 млн. лет назад.
Еще один редкий гриб, нуждающийся в защите человека, решеточник красный. Встречается он у нас изредка в оранжереях в кадках с тропическими растениями, где и был обнаружен в 1947 г. в Ленинграде, а в 1950 г. в Горно-Алтайске. В естественных условиях на территории СССР впервые был найден в Клинском р-не Московской обл. В настоящее время чаще всего встречаются на Кавказе и в Крыму, причем в основном на территории ботанических садов (Сухумского, Никитского). Кроме того, он отмечен во многих странах Европы, в южных областях Северной Америки и в Северной Африке. Но везде рассматривается как заносный вид. Вообще это тропический и субтропический гриб. Его родина — тропические леса и, возможно, субтропики Средиземноморья. Вероятнее всего, на территорию нашей страны он был завезен с тропическими растениями в виде спор или грибницы, а затем акклиматизировался и стал распространяться. Распространение решеточника красного сдерживается, однако, температурным фактором. Изучая распространение этого гриба в европейских странах, мы обнаружили, что он был отнесен к числу редких грибов еще Карлом Клузиусом — известным натуралистом конца XVI — начала XVII вв. Интересно, что рисунок Клузиуса (он его сделал 380 лет назад) настолько точен, что позволяет безошибочно определить этот гриб.
Мы подробно остановились на двух видах редких грибов, но их в списке значительно больше. Однако не весь список состоит из редких видов. Нуждаются в охране отнюдь не вымирающие виды, но такие, которым грозит исчезновение из-за того, что они имеют очень декоративное плодовое тело, привлекающее внимание, как и многие цветы. К таким видам, занесенным в "Красную книгу СССР", относятся ежевик коралловидный, грибы-бараны, или трутовики (грифола) разветвленный, или зонтичный, и листоватый, спарассис курчавый, или грибная капуста, диктиофора, или "дама с вуалью", мутинус собачий, цезарский гриб, сморчок степной и некоторые другие. Чтобы сохранить эти грибы, не следует их срывать, ведь каждый такой гриб даст сотни тысяч спор, которые гарантируют сохранность вида в целом.
Какие же меры по охране редких видов грибов предусматривает "Красная книга СССР"? Прежде всего — привлечь всеобщее внимание к охраняемым организмам. Здесь нужна большая просветительская работа. Хороший опыт в этом отношении имеют микологи Латвийской ССР. В широко распространенном в республике научно-популярном журнале из месяца в месяц печатаются короткие заметки об охраняемых на территории республики грибах, сопровождающиеся иллюстрациями, и, таким образом, население республики знакомится с темп грибами, которые надо беречь.
 Решеточник красный, найденный в окресностях Сухуми в 1983 г
Наибольшая роль в охране грибов принадлежит заповедникам и заказникам, где ограничено посещение, где сохраняются естественные условия мест обитания, что способствует сохранению на этих территориях многих видов животных, растений и, конечно, грибов.
Решеточник красный, найденный в окресностях Сухуми в 1983 г
Наибольшая роль в охране грибов принадлежит заповедникам и заказникам, где ограничено посещение, где сохраняются естественные условия мест обитания, что способствует сохранению на этих территориях многих видов животных, растений и, конечно, грибов.
 Решеточник красный из 'Кодекса Клузиуса' конца XVI в
Есть еще одна группа грибов, которая не вошла в "Красную книгу СССР", но которая также нуждается в бережном отношении. Это грибы, которые мы интенсивно собираем с пищевыми целями, — белый, рыжик, груздь и т. д. Для их охраны необходимо соблюдать правила сбора, не допускающие разрушения растительного покрова и мест обитания. Исследованиями установлено, что небрежный сбор грибов с разрушением лесной подстилки и повреждением грибницы ведет к значительному уменьшению воспроизводства грибов, сокращению их урожайности.
Таким образом, культура сбора грибов в значительной степени обеспечивает сохранность тех видов, которые пока еще встречаются в изобилии и которые природа щедро нам дарит. Широкой пропагандой правил сбора грибов и вообще правил поведения в лесу каждый может вложить свою лепту в благородное дело охраны природы.
Собирая грибы, сборщик-заготовитель и грибник-любитель должны всегда думать о том, чем они могут помочь лесу. Не следует собирать крупные, почти созревшие и особенно перезревшие грибы — они рассеют по лесу массу спор, и часть из них даст начало новым молодым сильным грибницам. Грибник-любитель может заняться полезным делом — подсевом грибов в лесу, что доступно каждому. Это уже практикуется рядом грибников и не без успеха. Способ этот старый и практиковался в России еще с конца прошлого столетия. Он состоит в том, что приметив место, где хорошо плодоносит какой-либо вид грибов, на похожее по составу пород деревьев место переносят небольшие, осторожно выкопанные кусочки грибницы, тщательно укладывают их в неглубокие ямки, прикрывают их лесной подстилкой (не землей) и слегка увлажняют. При влажной погоде смачивать грибницу надо только при посадке, а при сухой ее следует увлажнять (не поливать, а слегка сбрызгивать!) периодически, следя за тем, чтобы почва под подстилкой все время была влажной.
Решеточник красный из 'Кодекса Клузиуса' конца XVI в
Есть еще одна группа грибов, которая не вошла в "Красную книгу СССР", но которая также нуждается в бережном отношении. Это грибы, которые мы интенсивно собираем с пищевыми целями, — белый, рыжик, груздь и т. д. Для их охраны необходимо соблюдать правила сбора, не допускающие разрушения растительного покрова и мест обитания. Исследованиями установлено, что небрежный сбор грибов с разрушением лесной подстилки и повреждением грибницы ведет к значительному уменьшению воспроизводства грибов, сокращению их урожайности.
Таким образом, культура сбора грибов в значительной степени обеспечивает сохранность тех видов, которые пока еще встречаются в изобилии и которые природа щедро нам дарит. Широкой пропагандой правил сбора грибов и вообще правил поведения в лесу каждый может вложить свою лепту в благородное дело охраны природы.
Собирая грибы, сборщик-заготовитель и грибник-любитель должны всегда думать о том, чем они могут помочь лесу. Не следует собирать крупные, почти созревшие и особенно перезревшие грибы — они рассеют по лесу массу спор, и часть из них даст начало новым молодым сильным грибницам. Грибник-любитель может заняться полезным делом — подсевом грибов в лесу, что доступно каждому. Это уже практикуется рядом грибников и не без успеха. Способ этот старый и практиковался в России еще с конца прошлого столетия. Он состоит в том, что приметив место, где хорошо плодоносит какой-либо вид грибов, на похожее по составу пород деревьев место переносят небольшие, осторожно выкопанные кусочки грибницы, тщательно укладывают их в неглубокие ямки, прикрывают их лесной подстилкой (не землей) и слегка увлажняют. При влажной погоде смачивать грибницу надо только при посадке, а при сухой ее следует увлажнять (не поливать, а слегка сбрызгивать!) периодически, следя за тем, чтобы почва под подстилкой все время была влажной.
 Редкая находка из Львовской обл. — крупный экземпляр трутовика листоватого
Другой способ выращивания грибов в естественных условиях состоит в раскладывании на такие же места кусочков хорошо созревших плодовых тел, причем помещать их нужно на лесную подстилку, слегка разрыхлив ее, а по истечении 3-4 дней убрать эти кусочки и подстилку увлажнить.
Третий способ, особенно практиковавшийся у русских грибников, заключается в том, что перезрелые плодовые тела, например белых грибов, помещают в деревянной посуде в дождевую воду, выдерживают там около суток, затем размешивают получившуюся массу, процеживают ее через редкую ткань и этой водой, содержащей многочисленные споры гриба, поливают выбранный участок. Если брали, скажем, белый гриб из-под березы, то на поливаемом участке обязательно должны быть березы. Наиболее успешные результаты были получены при подсевах белых грибов, подберезовиков и рыжиков. Для посадки лучше использовать негустые березовые или дубовые рощи, а также молодые посадки (5-10-летние) сосен, елей, дубов. Уже на второй год при благоприятных условиях можно получить небольшой урожай грибов, правда, это будут еще или одиночные грибы, или небольшие семейки. Но спустя еще 2 года можно уже будет расчитывать на более значительный урожай.
Успешным оказался опыт разведения в лесных угодьях белых грибов любителем-грибоводом И. Веселковым из г. Винницы. Его способ заключается в том, что у зрелых (6-8-дневных) белых грибов отделяют трубчатую часть, измельчают на кусочки размером до 2 см3 и подсушивают 1-1,5 ч, перемешивая. Затем деревянной лопаточкой приподнимают верхнюю часть лесной подстилки, закладывают туда по 2-3 кусочка гриба и подстилку уплотняют. И. Веселкову удавалось получать от 64 до 260 кг грибов в пересчете на 1 га. Нужно отметить, что выращивание белых грибов вышеописанным способом теоретически еще не обосновано и поэтому на практике могут быть и неудачи, связанные с составом почвы, температурой, влажностью и т. п.
Редкая находка из Львовской обл. — крупный экземпляр трутовика листоватого
Другой способ выращивания грибов в естественных условиях состоит в раскладывании на такие же места кусочков хорошо созревших плодовых тел, причем помещать их нужно на лесную подстилку, слегка разрыхлив ее, а по истечении 3-4 дней убрать эти кусочки и подстилку увлажнить.
Третий способ, особенно практиковавшийся у русских грибников, заключается в том, что перезрелые плодовые тела, например белых грибов, помещают в деревянной посуде в дождевую воду, выдерживают там около суток, затем размешивают получившуюся массу, процеживают ее через редкую ткань и этой водой, содержащей многочисленные споры гриба, поливают выбранный участок. Если брали, скажем, белый гриб из-под березы, то на поливаемом участке обязательно должны быть березы. Наиболее успешные результаты были получены при подсевах белых грибов, подберезовиков и рыжиков. Для посадки лучше использовать негустые березовые или дубовые рощи, а также молодые посадки (5-10-летние) сосен, елей, дубов. Уже на второй год при благоприятных условиях можно получить небольшой урожай грибов, правда, это будут еще или одиночные грибы, или небольшие семейки. Но спустя еще 2 года можно уже будет расчитывать на более значительный урожай.
Успешным оказался опыт разведения в лесных угодьях белых грибов любителем-грибоводом И. Веселковым из г. Винницы. Его способ заключается в том, что у зрелых (6-8-дневных) белых грибов отделяют трубчатую часть, измельчают на кусочки размером до 2 см3 и подсушивают 1-1,5 ч, перемешивая. Затем деревянной лопаточкой приподнимают верхнюю часть лесной подстилки, закладывают туда по 2-3 кусочка гриба и подстилку уплотняют. И. Веселкову удавалось получать от 64 до 260 кг грибов в пересчете на 1 га. Нужно отметить, что выращивание белых грибов вышеописанным способом теоретически еще не обосновано и поэтому на практике могут быть и неудачи, связанные с составом почвы, температурой, влажностью и т. п.
 Гриб белый — один из самых ценных съедобных грибов. Пока мы не умеем выращивать его промышленным способом, но, соблюдая правила сбора грибов, подсаживая белый гриб в подходящих местах, мы можем сохранить и приумножить это богатство
Грибные плантации можно создавать и другим путем. На Волге издавна крестьяне-марийцы выращивали около своих домов вешенку и летний опенок. Для этого на каком-либо пустыре, поросшем высокой травой, крапивой, лебедой, помещали бревно вяза, березы, поливали их регулярно водой и ...урожай был обеспечен, так как в воздухе всегда есть споры этих грибов. Сейчас можно, конечно, не ждать заноса спор, а заражать субстрат кусочками грибницы, взятыми с уже зараженных пней или стволов, причем выгоднее заражать не древесину, а пни на лесосеках или не очень тонкий валежник. На них будут расти и плодоносить эти не опасные для живых деревьев грибы-сапротрофы и в то же время будет происходить биологическое разрушение лесных отходов.
Часто сборщиков грибов волнует вопрос: что лучше — срезать, ломать или выкручивать грибы? Ответ на него прост: собирайте грибы, как удобнее: трубчатые выкручивайте — так легче, пластинчатые срезайте или ломайте. Главное — не раскапывайте подстилку, чтобы не повредить грибницу. Ямку, образовавшуюся после того как снят гриб, надо присыпать подстилкой. При таких мерах осторожности грибница еще" неоднократно будет плодоносить на этом месте.
Ответственное отношение к природе стало у нас государственным делом. В сентябре 1972 г. Верховный Совет СССР признал необходимым включать во все планы развития народного хозяйства самостоятельный раздел по охране природы. Беречь и приумножать ее сокровища — обязанность каждого советского человека, записанная в Конституции СССР. Наши леса станут еще продуктивнее, а земли плодороднее, если все больше советских людей будет по-хозяйстки добиваться этого. Наш общий долг — сделать все, чтобы природа Родины вечно оставалась изобильной и прекрасной!
Гриб белый — один из самых ценных съедобных грибов. Пока мы не умеем выращивать его промышленным способом, но, соблюдая правила сбора грибов, подсаживая белый гриб в подходящих местах, мы можем сохранить и приумножить это богатство
Грибные плантации можно создавать и другим путем. На Волге издавна крестьяне-марийцы выращивали около своих домов вешенку и летний опенок. Для этого на каком-либо пустыре, поросшем высокой травой, крапивой, лебедой, помещали бревно вяза, березы, поливали их регулярно водой и ...урожай был обеспечен, так как в воздухе всегда есть споры этих грибов. Сейчас можно, конечно, не ждать заноса спор, а заражать субстрат кусочками грибницы, взятыми с уже зараженных пней или стволов, причем выгоднее заражать не древесину, а пни на лесосеках или не очень тонкий валежник. На них будут расти и плодоносить эти не опасные для живых деревьев грибы-сапротрофы и в то же время будет происходить биологическое разрушение лесных отходов.
Часто сборщиков грибов волнует вопрос: что лучше — срезать, ломать или выкручивать грибы? Ответ на него прост: собирайте грибы, как удобнее: трубчатые выкручивайте — так легче, пластинчатые срезайте или ломайте. Главное — не раскапывайте подстилку, чтобы не повредить грибницу. Ямку, образовавшуюся после того как снят гриб, надо присыпать подстилкой. При таких мерах осторожности грибница еще" неоднократно будет плодоносить на этом месте.
Ответственное отношение к природе стало у нас государственным делом. В сентябре 1972 г. Верховный Совет СССР признал необходимым включать во все планы развития народного хозяйства самостоятельный раздел по охране природы. Беречь и приумножать ее сокровища — обязанность каждого советского человека, записанная в Конституции СССР. Наши леса станут еще продуктивнее, а земли плодороднее, если все больше советских людей будет по-хозяйстки добиваться этого. Наш общий долг — сделать все, чтобы природа Родины вечно оставалась изобильной и прекрасной!
* * *
Грибы очень неохотно делятся с нами своими секретами, но люди никогда не искали легких путей в своих попытках разгадать тайны окружающего нас мира. Какие же конкретные задачи стоят сейчас перед микологами и теми учеными, а также работниками промышленности и сельского хозяйства, которые так или иначе связаны с грибами? Во-первых, это разработка и внедрение на современном научном и техническом уровне искусственного выращивания грибов — серьезного резерва в снабжении людей белковыми продуктами питания и полноценными кормами домашних животных и искусственно выращиваемых рыб. Работа эта ведется как в направлении расширения использования уже известных грибов, так и в разработке методов выращивания новых их видов. Во-вторых, это научная разработка и перевод на промышленную основу методов сбора, хранения и консервирования съедобных дикорастущих грибов. В-третьих, это важнейшая задача по созданию эффективных методов борьбы с грибами — вредителями сельскохозяйственных растений, леса и всевозможных материалов, особенно древесины. В-четвертых, микологи совместно с врачами, химиками, фармакологами и микробиологами должны продолжать и расширять поиск новых способов использования грибов для борьбы с болезнями людей, а также домашних животных. Необходимо усилить разъяснительную работу среди населения с целью предотвращения грибных отравлений и одновременно с этим продолжать поиски эффективных средств помощи при отравлениях грибными ядами. Грибы в основном жители леса, поэтому охрана лесов будет одновременно вкладом и в охрану наших грибных богатств.Грибная кухня
 Хорошая хозяйка всегда приготовит из грибов вкусную и разнообразную пищу
Грибы имеют невысокую калорийность из-за низкого содержания жиров и углеводов. Средняя калорийность 1 кг грибов не превышает 300-500 кал, в то время как в 1 кг жира 9100 кал, в таком же количестве мяса 4100 кал. В то же время грибы содержат большое количество белков, минеральных веществ, витаминов и многие другие ценные для человека вещества. Именно поэтому грибы все больше привлекают внимание людей, ведущих малоподвижный образ жизни и занятых интенсивной умственной работой. Теперь грибы начинают ценить не только как вкусную приправу к мясным и овощным блюдам, но и как самостоятельный продукт питания. Привлекательны грибы еще и тем, что содержат такие витамины, которые отсутствуют в других овощах или содержатся в них в малых количествах, например витамины В1, В2, В6, D, Н, а также никотиновую и пантотеновую кислоты.
По питательной ценности грибы занимают промежуточное положение между мясом и овощами и ценны как продукт, обогащающий бедную белком растительную пищу, например картофель и хлеб. Нельзя не учитывать и того, что отличные вкусовые качества грибов способны внести приятное разнообразие в наше питание.
Употребляя в пищу грибы, следует, однако, помнить, что хорошей их усвояемости мешает значительное содержание в них грибной клетчатки — хитина, который не только не переваривается в желудочно-кишечном тракте человека, но и затрудняет доступ пищеварительным сокам к перевариваемым веществам. Трудная усвояемость грибов вызвана, в частности, и тем, что грибные белки в основном труднорастворимы. Поэтому грибные блюда предназначаются только для здоровых людей.
Хорошая хозяйка всегда приготовит из грибов вкусную и разнообразную пищу
Грибы имеют невысокую калорийность из-за низкого содержания жиров и углеводов. Средняя калорийность 1 кг грибов не превышает 300-500 кал, в то время как в 1 кг жира 9100 кал, в таком же количестве мяса 4100 кал. В то же время грибы содержат большое количество белков, минеральных веществ, витаминов и многие другие ценные для человека вещества. Именно поэтому грибы все больше привлекают внимание людей, ведущих малоподвижный образ жизни и занятых интенсивной умственной работой. Теперь грибы начинают ценить не только как вкусную приправу к мясным и овощным блюдам, но и как самостоятельный продукт питания. Привлекательны грибы еще и тем, что содержат такие витамины, которые отсутствуют в других овощах или содержатся в них в малых количествах, например витамины В1, В2, В6, D, Н, а также никотиновую и пантотеновую кислоты.
По питательной ценности грибы занимают промежуточное положение между мясом и овощами и ценны как продукт, обогащающий бедную белком растительную пищу, например картофель и хлеб. Нельзя не учитывать и того, что отличные вкусовые качества грибов способны внести приятное разнообразие в наше питание.
Употребляя в пищу грибы, следует, однако, помнить, что хорошей их усвояемости мешает значительное содержание в них грибной клетчатки — хитина, который не только не переваривается в желудочно-кишечном тракте человека, но и затрудняет доступ пищеварительным сокам к перевариваемым веществам. Трудная усвояемость грибов вызвана, в частности, и тем, что грибные белки в основном труднорастворимы. Поэтому грибные блюда предназначаются только для здоровых людей.
Правила приготовления и хранения грибных блюд
Грибы относятся к скоропортящимся продуктам, поэтому их необходимо переработать в день сбора. Отравления грибами могут быть вызваны не только употреблением ядовитых грибов, но и неправильным использованием съедобных, безвредность которых установлена вековым опытом употребления их в пищу. Во избежание отравления съедобными грибами, а также для правильного использования грибов как продуктов питания необходимо строго соблюдать следующие правила: 1. нож для чистки грибов должен быть острым и желательно из нержавеющей стали; 2. не следует долго вымачивать грибы (за исключением видов с едким вкусом), их следует быстро промыть холодной водой и откинуть на решето, чтобы вода стекла; 3. очищенные, особенно промытые грибы сразу же следует подвергнуть окончательной обработке; 4. для варки грибов не рекомендуется пользоваться чугунной, медной или оловянной посудой; 5. грибные блюда употребляют в день их приготовления, но можно их хранить 24-30 ч, в холодильнике при температуре 2-4°С, качество подогретых грибных блюд сомнительно, поэтому готовят грибы для одноразового употребления; 6. нельзя оставлять на следующий день грибные блюда, приготовленные с картофелем; 7. в холодильнике лучше хранить свежие грибы, а не грибные блюда, если же нет возможности обработать грибы в первый день, их надо сохранять в холодильнике непромытыми и неразрезанными; 8. сушить грибы необходимо быстро при сравнительно высокой температуре и постоянной циркуляции воздуха, помня, что при медленной сушке они могут испортиться; 9. сушеные грибы и грибной порошок нужно хранить в сухом помещении со стабильной температурой; 10. нельзя употреблять в пищу грибы, съедобность которых вызывает сомнение; 11. условно съедобные грибы (строчки, сморчки, некоторые млечники и др.) необходимо во избежание отравления предварительно отварить в большом количестве воды, а затем промыть в холодной воде. Кулинары дают следующие общие рекомендации по приготовлению грибных блюд. Виды грибов, указанные ниже, в рецептах, предпочтительнее, но можно использовать и другие грибы. Грибной суп можно приготовить, например, из белых грибов, молодых подберезовиков, подосиновиков, шампиньонов и др. Грибы значительно улучшают вкусовые качества приготовляемой пищи. Нежные сыроежки или трубчатые грибы, прожаренные и добавленные в мясной фарш, придадут особый неповторимый вкус мясным тефтелям. Толчеными грибами или грибным порошком можно приправлять различные мясные и овощные блюда. Несколько свежих лисичек, добавленных в любой суп, улучшат его вкус, но, как правило, первые блюда нужно готовить из белых грибов, так как от них бульон не чернеет; годятся для супа также подберезовики и подосиновики. Чтобы грибы не чернели во время обработки, их опускают по мере чистки в кастрюлю с холодной слегка подсоленной водой, в которую добавляют немного уксуса. Консервированные грибы в большинстве блюд можно употреблять вместо свежих. В сухую погоду грибы можно сушить вот таким способом, развесив их на солнечной стороне дома
Если предполагается жаренье сушеных грибов, нужно с вечера, накануне приготовления, их вымыть, положить в молоко, а наутро нарезать и жарить обычным способом. Затем грибы заливают сметаной, солят и доводят до кипения. При таком приготовлении сушеные грибы ничем не уступят свежим. Супы из грибов не рекомендуется разогревать, а лучше есть сразу после приготовления, помня, что даже очень хорошие супы теряют после подогревания вкус. Тольку суточные щи (постные, на грибном отваре с кислой капустой) становятся вкуснее через сутки. Хранить такой суп рекомендуется в неокисляемой посуде (стеклянной, эмалированной, глиняной). Для тушения лучше всего использовать белые грибы, подберезовики, подосиновики, поддубовики, шампиньоны, летние и осенние опенки. Предназначенные для тушения очищенные и промытые грибы следует очень мелко нарезать, слегка обжарить на сильном огне в небольшом количестве сливочного масла или маргарина, затем добавить мелко нашинкованный репчатый лук, посолить, добавить сметану и тушить под крышкой до готовности на небольшом огне, доливая при необходимости воду.
В сухую погоду грибы можно сушить вот таким способом, развесив их на солнечной стороне дома
Если предполагается жаренье сушеных грибов, нужно с вечера, накануне приготовления, их вымыть, положить в молоко, а наутро нарезать и жарить обычным способом. Затем грибы заливают сметаной, солят и доводят до кипения. При таком приготовлении сушеные грибы ничем не уступят свежим. Супы из грибов не рекомендуется разогревать, а лучше есть сразу после приготовления, помня, что даже очень хорошие супы теряют после подогревания вкус. Тольку суточные щи (постные, на грибном отваре с кислой капустой) становятся вкуснее через сутки. Хранить такой суп рекомендуется в неокисляемой посуде (стеклянной, эмалированной, глиняной). Для тушения лучше всего использовать белые грибы, подберезовики, подосиновики, поддубовики, шампиньоны, летние и осенние опенки. Предназначенные для тушения очищенные и промытые грибы следует очень мелко нарезать, слегка обжарить на сильном огне в небольшом количестве сливочного масла или маргарина, затем добавить мелко нашинкованный репчатый лук, посолить, добавить сметану и тушить под крышкой до готовности на небольшом огне, доливая при необходимости воду.
Рецепты грибных блюд
Грибные супы
Картофельный суп со свежими грибами (русское блюдо). Очищенные грибы — белые, шампиньоны, маслята — ошпарить кипятком, откинуть на сито, нарезать ломтиками. Залить горячей водой, а затем варить так же, как обычный картофельный суп. Пропорция:500-600 г грибов, 800 г картофеля, 150 г кореньев, 1 луковица, 2 столовые ложки масла. Грибной суп с ушками (белорусское блюдо). Из вареных грибов и лука приготовить фарш. В отвар всыпать 2 ложки муки, прокипятить, получившийся суп-пюре заправить уксусом. Из оставшейся муки замесить пресное крутое тесто и сделать ушки с фаршем (наподобие пельменей), которые обжарить в растительном масле и положить при подаче в суп. Пропорция: 100 г сушеных грибов, 2-3 головки репчатого лука, 3 столовые ложки подсолнечного масла, 300 г пшеничной муки, уксус по вкусу. Суп-пюре из свежих шампиньонов (французское блюдо). 400 г свежих шампиньонов нарезать на мелкие кусочки и поджарить на сливочном масле в закрытом сосуде. Два стакана молока влить в отдельную кастрюльку и довести до кипения, а затем влить в сосуд с грибами и несколько минут оставить на огне. Затем все откинуть на дуршлаг и дать стечь отвару (его собирают). Грибы протереть и смешать с белым мясным соусом. Для соуса 2 столовые ложки муки поджарить в масле и туда же влить 2 стакана мясного бульона. Смесь довести до кипения, ввести в нее поджаренные в масле лук, морковь, петрушку, а также соль и перец по вкусу и варить 20- 25 мин, помешивая, чтобы не образовались комки. Жир и пену снять шумовкой. Шампиньоны в мясном соусе варят 6-10 мин. В ранее слитый с грибов отвар добавляют 4 желтка и после тщательного перемешивания вливают в суп. Затем суп нагревают до 60-65 С, помешивая. На стол подают с маслом и гренками из пшеничного хлеба. Грибной суп
Грибной суп с лапшой (русское блюдо).
Мелкие грибы разрезают пополам или на четыре части, более крупные нарезают кусочками. Нарезанные кружочками лук, петрушку и морковь отварить в воде или бульоне. Когда овощи будут почти готовы, положить грибы, варить на слабом огне 10-15 мин, затем добавить отдельно сваренную лапшу и заправить.
Пропорция: 200 г свежих шампиньонов или вешенки обыкновенной, 1 луковица, 1 корень петрушки, 1 маленький корень моркови, 1 л куриного бульона или воды, 1 столовая ложка сливочного масла, 60- 80 г лапши, измельченная зелень петрушки.
Грибная похлебка (финское блюдо).
Ячменную крупу сварить до готовности, затем добавить вычищенные грибы, молоко, масло. Похлебку довести до готовности и приправить солью по вкусу.
Состав: свежие молодые трубчатые грибы, ячневая крупа, молоко, вода, сливочное масло, соль.
Грибной суп (финское блюдо).
Рубленые грибы и лук подрумянить на маргарине в кастрюле, после чего добавить муку и бульон. Суп варить примерно полчаса и заправить смесью сливок и взбитого желтка при интенсивном помешивании. Соль добавить по вкусу и перед подачей на стол блюда заправить петрушкой.
Пропорция: 1 кг свежих грибов, 1 луковица, 50 г маргарина, 2-3 столовые ложки пшеничной муки, 2 мясных бульонных кубика, 1 яичный желток, 0,1 л сливок, соль, петрушка.
Суп из опенков осенних (русское блюдо).
Растопить масло в кастрюле и добавить промытые нарезанные грибы и лук. Варить на медленном огне 20-30 мин, после чего загустить пшеничной мукой, разведенной в холодной воде до желаемой консистенции. Дать супу покипеть еще несколько минут, после чего добавить сметану и специи по вкусу, к столу подавать обильно посыпанным мелко нарезанной петрушкой.
Пропорция: 0,6 кг шляпок опят осенних, 1 стакан мелко нарубленного лука, 2 столовые ложки сливочного масла, 1 л мясного бульона, 2-3 столовые ложки пшеничной муки, 0,1 л сметаны, соль, перец, мелко нарезанная петрушка.
Грибной бульон.
Тщательно промыть сухие грибы. Положить в кастрюлю и залить небольшим количеством воды. Через 2 ч влить остальную воду и положить очищенную луковицу. Варить на слабом огне до полного, размягчения грибов. Вынуть грибы, сполоснуть холодной водой и нашинковать. Бульон процедить. При варке супа на грибном бульоне измельченные грибы, предварительно слегка поджаренные в сливочном масле с небольшим количеством мелко нашинкованного лука, добавляют перед окончанием варки, после засыпки бульона картофелем, крупой или макаронными изделиями.
Пропорция: 50 г сухих грибов, 2,5 л воды, 2 луковицы, 15 г сливочного масла, соль, перец, укроп.
Суп из кабачков с грибами (болгарское блюдо).
Очистить, вымыть и нарезать на пластинки 500 г кабачков и 450-500 г свежих грибов. Мелко нарезанные ножки грибов, 1-2 морковки и головку лука поставить тушить в 1-2 столовых ложках масла. Когда они станут мягкими, залить 2 л костного бульона или горячей водой и поставить на медленный огонь. Добавить грибы, 4-5 шт. мелко нарезанного картофеля, затем кабачки и 2-3 помидора, очищенные и натертые на крупной терке. Заправить суп можно петрушкой и перцем.
Солянка на грибном бульоне. Нашинковать и слегка поджарить лук, добавив в конце жарения томат-пюре. Сварить грибы в небольшом количестве воды, после готовности вынуть их из бульона и промыть холодной водой. Нарезанные кусочками грибы сложить в посуду, добавить мелко нарезанные (без кожицы) соленые огурцы, слегка поджаренный лук, лавровый лист, перец горошком и заправить предварительно подготовленным грибным бульоном. Добавить необходимое количество горячей воды и варить 10 мин. Подавать со сметаной, ломтиками лимона, зеленью петрушки или укропа.
Пропорция: 500 г грибов, 2 луковицы, по 2 столовые ложки томата-пюре и масла или маргарина, 100 г сметаны, % лимона, 150-200 г соленых огурцов.
Суп-пюре из свежих грибов (болгарское блюдо).
700 г свежих грибов очистить, тщательно промыть и пропустить через мясорубку. В смолотые грибы положить 1 столовую ложку сливочного масла и тушить 25-30 мин вместе с мелко нарезанными морковью и головкой лука, накрыв кастрюлю крышкой. Когда морковь станет мягкой, добавить немного воды и варить на слабом огне. Дальнейший способ приготовления такой же, как и других супов-пюре. Перед тем как пропустить грибы через мясорубку, отделяют несколько шляпок, нарезают их соломкой и варят в слегка подсоленном бульоне. Сваренные грибы кладут в тарелки и заливают супом. Суп можно подавать с гренками.
Суп грибной (румынское блюдо).
Свежие молодые грибы очистить, вымыть и нарезать ломтиками. Дать стечь воде и тушить с 1/2 чайной ложки сливочного масла и мелко нарубленной зеленью петрушки. Посолить, прибавить перец. Поджарить 1/2 столовой ложки муки с 1/2 чайной ложки сливочного масла и развести овощным отваром. Положить грибы и суп еще поварить, перед подачей заправить желтком.
Пропорция: 3 л воды, 500 г грибов, 1 чайная ложка сливочного масла, 1/2 столовой ложки муки, соль, перец, 1 желток.
Суп из лисичек (старинное русское блюдо).
Лисички (500 г) вымыть, нарезать 100 г шпига, истолочь и тушить в нем мелко нарезанный лук в течение 10 мин, чтобы он стал полумягким. Затем соединить грибы с луком и тушить еще 45 мин. После этого грибы залить 3 л кипятка, посолить и кипятить 30 мин. Чайную ложку муки развести со сметаной и заправить грибы. При желании посыпать перцем по вкусу.
Суп-пюре из свежих шампиньонов.
Свежие шампиньоны очистить, вымыть, пропустить через мясорубку, сложить в кастрюлю, добавить столовую ложку масла, разрезанную вдоль на две части морковь и целую луковицу, накрыть крышкой и тушить 40-45 мин, потом добавить стакан воды и прокипятить. В суповой кастрюле слегка поджарить 2 столовые ложки муки с 2 столовыми ложками масла, развести 4 стакана горячего молока и стаканом овощного отвара или воды, вскипятить, смешать с тушеными шампиньонами (удалив морковь и луковицу) и варить 15-20 мин. После варки добавить по вкусу соль, заправить суп маслом и яичным желтком, смешанным со сливками или молоком. Отдельно подавать гренки. Так же можно приготовить суп из свежих белых грибов или сморчков.
Пропорция: на 600 г свежих грибов 2 столовые ложки муки, 4 стакана молока, 3 столовые ложки масла, по 1 шт. моркови и лука. Для заправки — 2 яичных желтка и 1 стакан сливок или молока.
Суп перловый с шампиньонами (русское блюдо).
Положить в воду крупу, картофель, морковь, коренья петрушки и сельдерея, посолить и поставить варить. Когда крупа разварится, опустить в суп промытые целые грибы. На растительном масле поджарить мелко нарезанный лук, заправить его 1 столовой ложкой муки и добавить в суп. Как только грибы станут мягкими, их нужно мелко порубить, разложить в тарелки, залить бульоном и подать к столу. Пропорция: 500 г шампиньонов, 2-3 столовые ложки перловой крупы, 4-5 шт. картофеля, 2-3 луковицы, 2 моркови, по 1 корню петрушки и сельдерея, 2-3 столовые ложки подсолнечного масла, 1 столовая ложка муки.
Брюссельский суп из шампиньонов.
Грибы очистить, промыть, пропустить через мясорубку и потушить в масле вместе с натертым луком в течение 10 мин на медленном огне. Добавить муку, влить бульон и приправить его. Суп снять с огня, добавить сливки, посыпать зеленью петрушки и крупно нарубленными яйцами.
Пропорция: 500 г шампиньонов, 2 столовые ложки масла, 1 луковица, 1 столовая ложка муки, 1 л бульона из костей, соль, перец, 1 стакан сливок, 2 сваренных вкрутую яйца, 1 столовая ложка мелко нарубленной зелени петрушки.
Грибной суп
Грибной суп с лапшой (русское блюдо).
Мелкие грибы разрезают пополам или на четыре части, более крупные нарезают кусочками. Нарезанные кружочками лук, петрушку и морковь отварить в воде или бульоне. Когда овощи будут почти готовы, положить грибы, варить на слабом огне 10-15 мин, затем добавить отдельно сваренную лапшу и заправить.
Пропорция: 200 г свежих шампиньонов или вешенки обыкновенной, 1 луковица, 1 корень петрушки, 1 маленький корень моркови, 1 л куриного бульона или воды, 1 столовая ложка сливочного масла, 60- 80 г лапши, измельченная зелень петрушки.
Грибная похлебка (финское блюдо).
Ячменную крупу сварить до готовности, затем добавить вычищенные грибы, молоко, масло. Похлебку довести до готовности и приправить солью по вкусу.
Состав: свежие молодые трубчатые грибы, ячневая крупа, молоко, вода, сливочное масло, соль.
Грибной суп (финское блюдо).
Рубленые грибы и лук подрумянить на маргарине в кастрюле, после чего добавить муку и бульон. Суп варить примерно полчаса и заправить смесью сливок и взбитого желтка при интенсивном помешивании. Соль добавить по вкусу и перед подачей на стол блюда заправить петрушкой.
Пропорция: 1 кг свежих грибов, 1 луковица, 50 г маргарина, 2-3 столовые ложки пшеничной муки, 2 мясных бульонных кубика, 1 яичный желток, 0,1 л сливок, соль, петрушка.
Суп из опенков осенних (русское блюдо).
Растопить масло в кастрюле и добавить промытые нарезанные грибы и лук. Варить на медленном огне 20-30 мин, после чего загустить пшеничной мукой, разведенной в холодной воде до желаемой консистенции. Дать супу покипеть еще несколько минут, после чего добавить сметану и специи по вкусу, к столу подавать обильно посыпанным мелко нарезанной петрушкой.
Пропорция: 0,6 кг шляпок опят осенних, 1 стакан мелко нарубленного лука, 2 столовые ложки сливочного масла, 1 л мясного бульона, 2-3 столовые ложки пшеничной муки, 0,1 л сметаны, соль, перец, мелко нарезанная петрушка.
Грибной бульон.
Тщательно промыть сухие грибы. Положить в кастрюлю и залить небольшим количеством воды. Через 2 ч влить остальную воду и положить очищенную луковицу. Варить на слабом огне до полного, размягчения грибов. Вынуть грибы, сполоснуть холодной водой и нашинковать. Бульон процедить. При варке супа на грибном бульоне измельченные грибы, предварительно слегка поджаренные в сливочном масле с небольшим количеством мелко нашинкованного лука, добавляют перед окончанием варки, после засыпки бульона картофелем, крупой или макаронными изделиями.
Пропорция: 50 г сухих грибов, 2,5 л воды, 2 луковицы, 15 г сливочного масла, соль, перец, укроп.
Суп из кабачков с грибами (болгарское блюдо).
Очистить, вымыть и нарезать на пластинки 500 г кабачков и 450-500 г свежих грибов. Мелко нарезанные ножки грибов, 1-2 морковки и головку лука поставить тушить в 1-2 столовых ложках масла. Когда они станут мягкими, залить 2 л костного бульона или горячей водой и поставить на медленный огонь. Добавить грибы, 4-5 шт. мелко нарезанного картофеля, затем кабачки и 2-3 помидора, очищенные и натертые на крупной терке. Заправить суп можно петрушкой и перцем.
Солянка на грибном бульоне. Нашинковать и слегка поджарить лук, добавив в конце жарения томат-пюре. Сварить грибы в небольшом количестве воды, после готовности вынуть их из бульона и промыть холодной водой. Нарезанные кусочками грибы сложить в посуду, добавить мелко нарезанные (без кожицы) соленые огурцы, слегка поджаренный лук, лавровый лист, перец горошком и заправить предварительно подготовленным грибным бульоном. Добавить необходимое количество горячей воды и варить 10 мин. Подавать со сметаной, ломтиками лимона, зеленью петрушки или укропа.
Пропорция: 500 г грибов, 2 луковицы, по 2 столовые ложки томата-пюре и масла или маргарина, 100 г сметаны, % лимона, 150-200 г соленых огурцов.
Суп-пюре из свежих грибов (болгарское блюдо).
700 г свежих грибов очистить, тщательно промыть и пропустить через мясорубку. В смолотые грибы положить 1 столовую ложку сливочного масла и тушить 25-30 мин вместе с мелко нарезанными морковью и головкой лука, накрыв кастрюлю крышкой. Когда морковь станет мягкой, добавить немного воды и варить на слабом огне. Дальнейший способ приготовления такой же, как и других супов-пюре. Перед тем как пропустить грибы через мясорубку, отделяют несколько шляпок, нарезают их соломкой и варят в слегка подсоленном бульоне. Сваренные грибы кладут в тарелки и заливают супом. Суп можно подавать с гренками.
Суп грибной (румынское блюдо).
Свежие молодые грибы очистить, вымыть и нарезать ломтиками. Дать стечь воде и тушить с 1/2 чайной ложки сливочного масла и мелко нарубленной зеленью петрушки. Посолить, прибавить перец. Поджарить 1/2 столовой ложки муки с 1/2 чайной ложки сливочного масла и развести овощным отваром. Положить грибы и суп еще поварить, перед подачей заправить желтком.
Пропорция: 3 л воды, 500 г грибов, 1 чайная ложка сливочного масла, 1/2 столовой ложки муки, соль, перец, 1 желток.
Суп из лисичек (старинное русское блюдо).
Лисички (500 г) вымыть, нарезать 100 г шпига, истолочь и тушить в нем мелко нарезанный лук в течение 10 мин, чтобы он стал полумягким. Затем соединить грибы с луком и тушить еще 45 мин. После этого грибы залить 3 л кипятка, посолить и кипятить 30 мин. Чайную ложку муки развести со сметаной и заправить грибы. При желании посыпать перцем по вкусу.
Суп-пюре из свежих шампиньонов.
Свежие шампиньоны очистить, вымыть, пропустить через мясорубку, сложить в кастрюлю, добавить столовую ложку масла, разрезанную вдоль на две части морковь и целую луковицу, накрыть крышкой и тушить 40-45 мин, потом добавить стакан воды и прокипятить. В суповой кастрюле слегка поджарить 2 столовые ложки муки с 2 столовыми ложками масла, развести 4 стакана горячего молока и стаканом овощного отвара или воды, вскипятить, смешать с тушеными шампиньонами (удалив морковь и луковицу) и варить 15-20 мин. После варки добавить по вкусу соль, заправить суп маслом и яичным желтком, смешанным со сливками или молоком. Отдельно подавать гренки. Так же можно приготовить суп из свежих белых грибов или сморчков.
Пропорция: на 600 г свежих грибов 2 столовые ложки муки, 4 стакана молока, 3 столовые ложки масла, по 1 шт. моркови и лука. Для заправки — 2 яичных желтка и 1 стакан сливок или молока.
Суп перловый с шампиньонами (русское блюдо).
Положить в воду крупу, картофель, морковь, коренья петрушки и сельдерея, посолить и поставить варить. Когда крупа разварится, опустить в суп промытые целые грибы. На растительном масле поджарить мелко нарезанный лук, заправить его 1 столовой ложкой муки и добавить в суп. Как только грибы станут мягкими, их нужно мелко порубить, разложить в тарелки, залить бульоном и подать к столу. Пропорция: 500 г шампиньонов, 2-3 столовые ложки перловой крупы, 4-5 шт. картофеля, 2-3 луковицы, 2 моркови, по 1 корню петрушки и сельдерея, 2-3 столовые ложки подсолнечного масла, 1 столовая ложка муки.
Брюссельский суп из шампиньонов.
Грибы очистить, промыть, пропустить через мясорубку и потушить в масле вместе с натертым луком в течение 10 мин на медленном огне. Добавить муку, влить бульон и приправить его. Суп снять с огня, добавить сливки, посыпать зеленью петрушки и крупно нарубленными яйцами.
Пропорция: 500 г шампиньонов, 2 столовые ложки масла, 1 луковица, 1 столовая ложка муки, 1 л бульона из костей, соль, перец, 1 стакан сливок, 2 сваренных вкрутую яйца, 1 столовая ложка мелко нарубленной зелени петрушки.
Рецепты грибных блюд
Грибные супы
Картофельный суп со свежими грибами (русское блюдо). Очищенные грибы — белые, шампиньоны, маслята — ошпарить кипятком, откинуть на сито, нарезать ломтиками. Залить горячей водой, а затем варить так же, как обычный картофельный суп. Пропорция:500-600 г грибов, 800 г картофеля, 150 г кореньев, 1 луковица, 2 столовые ложки масла. Грибной суп с ушками (белорусское блюдо). Из вареных грибов и лука приготовить фарш. В отвар всыпать 2 ложки муки, прокипятить, получившийся суп-пюре заправить уксусом. Из оставшейся муки замесить пресное крутое тесто и сделать ушки с фаршем (наподобие пельменей), которые обжарить в растительном масле и положить при подаче в суп. Пропорция: 100 г сушеных грибов, 2-3 головки репчатого лука, 3 столовые ложки подсолнечного масла, 300 г пшеничной муки, уксус по вкусу. Суп-пюре из свежих шампиньонов (французское блюдо). 400 г свежих шампиньонов нарезать на мелкие кусочки и поджарить на сливочном масле в закрытом сосуде. Два стакана молока влить в отдельную кастрюльку и довести до кипения, а затем влить в сосуд с грибами и несколько минут оставить на огне. Затем все откинуть на дуршлаг и дать стечь отвару (его собирают). Грибы протереть и смешать с белым мясным соусом. Для соуса 2 столовые ложки муки поджарить в масле и туда же влить 2 стакана мясного бульона. Смесь довести до кипения, ввести в нее поджаренные в масле лук, морковь, петрушку, а также соль и перец по вкусу и варить 20- 25 мин, помешивая, чтобы не образовались комки. Жир и пену снять шумовкой. Шампиньоны в мясном соусе варят 6-10 мин. В ранее слитый с грибов отвар добавляют 4 желтка и после тщательного перемешивания вливают в суп. Затем суп нагревают до 60-65 С, помешивая. На стол подают с маслом и гренками из пшеничного хлеба. Грибной суп
Грибной суп с лапшой (русское блюдо).
Мелкие грибы разрезают пополам или на четыре части, более крупные нарезают кусочками. Нарезанные кружочками лук, петрушку и морковь отварить в воде или бульоне. Когда овощи будут почти готовы, положить грибы, варить на слабом огне 10-15 мин, затем добавить отдельно сваренную лапшу и заправить.
Пропорция: 200 г свежих шампиньонов или вешенки обыкновенной, 1 луковица, 1 корень петрушки, 1 маленький корень моркови, 1 л куриного бульона или воды, 1 столовая ложка сливочного масла, 60- 80 г лапши, измельченная зелень петрушки.
Грибная похлебка (финское блюдо).
Ячменную крупу сварить до готовности, затем добавить вычищенные грибы, молоко, масло. Похлебку довести до готовности и приправить солью по вкусу.
Состав: свежие молодые трубчатые грибы, ячневая крупа, молоко, вода, сливочное масло, соль.
Грибной суп (финское блюдо).
Рубленые грибы и лук подрумянить на маргарине в кастрюле, после чего добавить муку и бульон. Суп варить примерно полчаса и заправить смесью сливок и взбитого желтка при интенсивном помешивании. Соль добавить по вкусу и перед подачей на стол блюда заправить петрушкой.
Пропорция: 1 кг свежих грибов, 1 луковица, 50 г маргарина, 2-3 столовые ложки пшеничной муки, 2 мясных бульонных кубика, 1 яичный желток, 0,1 л сливок, соль, петрушка.
Суп из опенков осенних (русское блюдо).
Растопить масло в кастрюле и добавить промытые нарезанные грибы и лук. Варить на медленном огне 20-30 мин, после чего загустить пшеничной мукой, разведенной в холодной воде до желаемой консистенции. Дать супу покипеть еще несколько минут, после чего добавить сметану и специи по вкусу, к столу подавать обильно посыпанным мелко нарезанной петрушкой.
Пропорция: 0,6 кг шляпок опят осенних, 1 стакан мелко нарубленного лука, 2 столовые ложки сливочного масла, 1 л мясного бульона, 2-3 столовые ложки пшеничной муки, 0,1 л сметаны, соль, перец, мелко нарезанная петрушка.
Грибной бульон.
Тщательно промыть сухие грибы. Положить в кастрюлю и залить небольшим количеством воды. Через 2 ч влить остальную воду и положить очищенную луковицу. Варить на слабом огне до полного, размягчения грибов. Вынуть грибы, сполоснуть холодной водой и нашинковать. Бульон процедить. При варке супа на грибном бульоне измельченные грибы, предварительно слегка поджаренные в сливочном масле с небольшим количеством мелко нашинкованного лука, добавляют перед окончанием варки, после засыпки бульона картофелем, крупой или макаронными изделиями.
Пропорция: 50 г сухих грибов, 2,5 л воды, 2 луковицы, 15 г сливочного масла, соль, перец, укроп.
Суп из кабачков с грибами (болгарское блюдо).
Очистить, вымыть и нарезать на пластинки 500 г кабачков и 450-500 г свежих грибов. Мелко нарезанные ножки грибов, 1-2 морковки и головку лука поставить тушить в 1-2 столовых ложках масла. Когда они станут мягкими, залить 2 л костного бульона или горячей водой и поставить на медленный огонь. Добавить грибы, 4-5 шт. мелко нарезанного картофеля, затем кабачки и 2-3 помидора, очищенные и натертые на крупной терке. Заправить суп можно петрушкой и перцем.
Солянка на грибном бульоне. Нашинковать и слегка поджарить лук, добавив в конце жарения томат-пюре. Сварить грибы в небольшом количестве воды, после готовности вынуть их из бульона и промыть холодной водой. Нарезанные кусочками грибы сложить в посуду, добавить мелко нарезанные (без кожицы) соленые огурцы, слегка поджаренный лук, лавровый лист, перец горошком и заправить предварительно подготовленным грибным бульоном. Добавить необходимое количество горячей воды и варить 10 мин. Подавать со сметаной, ломтиками лимона, зеленью петрушки или укропа.
Пропорция: 500 г грибов, 2 луковицы, по 2 столовые ложки томата-пюре и масла или маргарина, 100 г сметаны, % лимона, 150-200 г соленых огурцов.
Суп-пюре из свежих грибов (болгарское блюдо).
700 г свежих грибов очистить, тщательно промыть и пропустить через мясорубку. В смолотые грибы положить 1 столовую ложку сливочного масла и тушить 25-30 мин вместе с мелко нарезанными морковью и головкой лука, накрыв кастрюлю крышкой. Когда морковь станет мягкой, добавить немного воды и варить на слабом огне. Дальнейший способ приготовления такой же, как и других супов-пюре. Перед тем как пропустить грибы через мясорубку, отделяют несколько шляпок, нарезают их соломкой и варят в слегка подсоленном бульоне. Сваренные грибы кладут в тарелки и заливают супом. Суп можно подавать с гренками.
Суп грибной (румынское блюдо).
Свежие молодые грибы очистить, вымыть и нарезать ломтиками. Дать стечь воде и тушить с 1/2 чайной ложки сливочного масла и мелко нарубленной зеленью петрушки. Посолить, прибавить перец. Поджарить 1/2 столовой ложки муки с 1/2 чайной ложки сливочного масла и развести овощным отваром. Положить грибы и суп еще поварить, перед подачей заправить желтком.
Пропорция: 3 л воды, 500 г грибов, 1 чайная ложка сливочного масла, 1/2 столовой ложки муки, соль, перец, 1 желток.
Суп из лисичек (старинное русское блюдо).
Лисички (500 г) вымыть, нарезать 100 г шпига, истолочь и тушить в нем мелко нарезанный лук в течение 10 мин, чтобы он стал полумягким. Затем соединить грибы с луком и тушить еще 45 мин. После этого грибы залить 3 л кипятка, посолить и кипятить 30 мин. Чайную ложку муки развести со сметаной и заправить грибы. При желании посыпать перцем по вкусу.
Суп-пюре из свежих шампиньонов.
Свежие шампиньоны очистить, вымыть, пропустить через мясорубку, сложить в кастрюлю, добавить столовую ложку масла, разрезанную вдоль на две части морковь и целую луковицу, накрыть крышкой и тушить 40-45 мин, потом добавить стакан воды и прокипятить. В суповой кастрюле слегка поджарить 2 столовые ложки муки с 2 столовыми ложками масла, развести 4 стакана горячего молока и стаканом овощного отвара или воды, вскипятить, смешать с тушеными шампиньонами (удалив морковь и луковицу) и варить 15-20 мин. После варки добавить по вкусу соль, заправить суп маслом и яичным желтком, смешанным со сливками или молоком. Отдельно подавать гренки. Так же можно приготовить суп из свежих белых грибов или сморчков.
Пропорция: на 600 г свежих грибов 2 столовые ложки муки, 4 стакана молока, 3 столовые ложки масла, по 1 шт. моркови и лука. Для заправки — 2 яичных желтка и 1 стакан сливок или молока.
Суп перловый с шампиньонами (русское блюдо).
Положить в воду крупу, картофель, морковь, коренья петрушки и сельдерея, посолить и поставить варить. Когда крупа разварится, опустить в суп промытые целые грибы. На растительном масле поджарить мелко нарезанный лук, заправить его 1 столовой ложкой муки и добавить в суп. Как только грибы станут мягкими, их нужно мелко порубить, разложить в тарелки, залить бульоном и подать к столу. Пропорция: 500 г шампиньонов, 2-3 столовые ложки перловой крупы, 4-5 шт. картофеля, 2-3 луковицы, 2 моркови, по 1 корню петрушки и сельдерея, 2-3 столовые ложки подсолнечного масла, 1 столовая ложка муки.
Брюссельский суп из шампиньонов.
Грибы очистить, промыть, пропустить через мясорубку и потушить в масле вместе с натертым луком в течение 10 мин на медленном огне. Добавить муку, влить бульон и приправить его. Суп снять с огня, добавить сливки, посыпать зеленью петрушки и крупно нарубленными яйцами.
Пропорция: 500 г шампиньонов, 2 столовые ложки масла, 1 луковица, 1 столовая ложка муки, 1 л бульона из костей, соль, перец, 1 стакан сливок, 2 сваренных вкрутую яйца, 1 столовая ложка мелко нарубленной зелени петрушки.
Грибной суп
Грибной суп с лапшой (русское блюдо).
Мелкие грибы разрезают пополам или на четыре части, более крупные нарезают кусочками. Нарезанные кружочками лук, петрушку и морковь отварить в воде или бульоне. Когда овощи будут почти готовы, положить грибы, варить на слабом огне 10-15 мин, затем добавить отдельно сваренную лапшу и заправить.
Пропорция: 200 г свежих шампиньонов или вешенки обыкновенной, 1 луковица, 1 корень петрушки, 1 маленький корень моркови, 1 л куриного бульона или воды, 1 столовая ложка сливочного масла, 60- 80 г лапши, измельченная зелень петрушки.
Грибная похлебка (финское блюдо).
Ячменную крупу сварить до готовности, затем добавить вычищенные грибы, молоко, масло. Похлебку довести до готовности и приправить солью по вкусу.
Состав: свежие молодые трубчатые грибы, ячневая крупа, молоко, вода, сливочное масло, соль.
Грибной суп (финское блюдо).
Рубленые грибы и лук подрумянить на маргарине в кастрюле, после чего добавить муку и бульон. Суп варить примерно полчаса и заправить смесью сливок и взбитого желтка при интенсивном помешивании. Соль добавить по вкусу и перед подачей на стол блюда заправить петрушкой.
Пропорция: 1 кг свежих грибов, 1 луковица, 50 г маргарина, 2-3 столовые ложки пшеничной муки, 2 мясных бульонных кубика, 1 яичный желток, 0,1 л сливок, соль, петрушка.
Суп из опенков осенних (русское блюдо).
Растопить масло в кастрюле и добавить промытые нарезанные грибы и лук. Варить на медленном огне 20-30 мин, после чего загустить пшеничной мукой, разведенной в холодной воде до желаемой консистенции. Дать супу покипеть еще несколько минут, после чего добавить сметану и специи по вкусу, к столу подавать обильно посыпанным мелко нарезанной петрушкой.
Пропорция: 0,6 кг шляпок опят осенних, 1 стакан мелко нарубленного лука, 2 столовые ложки сливочного масла, 1 л мясного бульона, 2-3 столовые ложки пшеничной муки, 0,1 л сметаны, соль, перец, мелко нарезанная петрушка.
Грибной бульон.
Тщательно промыть сухие грибы. Положить в кастрюлю и залить небольшим количеством воды. Через 2 ч влить остальную воду и положить очищенную луковицу. Варить на слабом огне до полного, размягчения грибов. Вынуть грибы, сполоснуть холодной водой и нашинковать. Бульон процедить. При варке супа на грибном бульоне измельченные грибы, предварительно слегка поджаренные в сливочном масле с небольшим количеством мелко нашинкованного лука, добавляют перед окончанием варки, после засыпки бульона картофелем, крупой или макаронными изделиями.
Пропорция: 50 г сухих грибов, 2,5 л воды, 2 луковицы, 15 г сливочного масла, соль, перец, укроп.
Суп из кабачков с грибами (болгарское блюдо).
Очистить, вымыть и нарезать на пластинки 500 г кабачков и 450-500 г свежих грибов. Мелко нарезанные ножки грибов, 1-2 морковки и головку лука поставить тушить в 1-2 столовых ложках масла. Когда они станут мягкими, залить 2 л костного бульона или горячей водой и поставить на медленный огонь. Добавить грибы, 4-5 шт. мелко нарезанного картофеля, затем кабачки и 2-3 помидора, очищенные и натертые на крупной терке. Заправить суп можно петрушкой и перцем.
Солянка на грибном бульоне. Нашинковать и слегка поджарить лук, добавив в конце жарения томат-пюре. Сварить грибы в небольшом количестве воды, после готовности вынуть их из бульона и промыть холодной водой. Нарезанные кусочками грибы сложить в посуду, добавить мелко нарезанные (без кожицы) соленые огурцы, слегка поджаренный лук, лавровый лист, перец горошком и заправить предварительно подготовленным грибным бульоном. Добавить необходимое количество горячей воды и варить 10 мин. Подавать со сметаной, ломтиками лимона, зеленью петрушки или укропа.
Пропорция: 500 г грибов, 2 луковицы, по 2 столовые ложки томата-пюре и масла или маргарина, 100 г сметаны, % лимона, 150-200 г соленых огурцов.
Суп-пюре из свежих грибов (болгарское блюдо).
700 г свежих грибов очистить, тщательно промыть и пропустить через мясорубку. В смолотые грибы положить 1 столовую ложку сливочного масла и тушить 25-30 мин вместе с мелко нарезанными морковью и головкой лука, накрыв кастрюлю крышкой. Когда морковь станет мягкой, добавить немного воды и варить на слабом огне. Дальнейший способ приготовления такой же, как и других супов-пюре. Перед тем как пропустить грибы через мясорубку, отделяют несколько шляпок, нарезают их соломкой и варят в слегка подсоленном бульоне. Сваренные грибы кладут в тарелки и заливают супом. Суп можно подавать с гренками.
Суп грибной (румынское блюдо).
Свежие молодые грибы очистить, вымыть и нарезать ломтиками. Дать стечь воде и тушить с 1/2 чайной ложки сливочного масла и мелко нарубленной зеленью петрушки. Посолить, прибавить перец. Поджарить 1/2 столовой ложки муки с 1/2 чайной ложки сливочного масла и развести овощным отваром. Положить грибы и суп еще поварить, перед подачей заправить желтком.
Пропорция: 3 л воды, 500 г грибов, 1 чайная ложка сливочного масла, 1/2 столовой ложки муки, соль, перец, 1 желток.
Суп из лисичек (старинное русское блюдо).
Лисички (500 г) вымыть, нарезать 100 г шпига, истолочь и тушить в нем мелко нарезанный лук в течение 10 мин, чтобы он стал полумягким. Затем соединить грибы с луком и тушить еще 45 мин. После этого грибы залить 3 л кипятка, посолить и кипятить 30 мин. Чайную ложку муки развести со сметаной и заправить грибы. При желании посыпать перцем по вкусу.
Суп-пюре из свежих шампиньонов.
Свежие шампиньоны очистить, вымыть, пропустить через мясорубку, сложить в кастрюлю, добавить столовую ложку масла, разрезанную вдоль на две части морковь и целую луковицу, накрыть крышкой и тушить 40-45 мин, потом добавить стакан воды и прокипятить. В суповой кастрюле слегка поджарить 2 столовые ложки муки с 2 столовыми ложками масла, развести 4 стакана горячего молока и стаканом овощного отвара или воды, вскипятить, смешать с тушеными шампиньонами (удалив морковь и луковицу) и варить 15-20 мин. После варки добавить по вкусу соль, заправить суп маслом и яичным желтком, смешанным со сливками или молоком. Отдельно подавать гренки. Так же можно приготовить суп из свежих белых грибов или сморчков.
Пропорция: на 600 г свежих грибов 2 столовые ложки муки, 4 стакана молока, 3 столовые ложки масла, по 1 шт. моркови и лука. Для заправки — 2 яичных желтка и 1 стакан сливок или молока.
Суп перловый с шампиньонами (русское блюдо).
Положить в воду крупу, картофель, морковь, коренья петрушки и сельдерея, посолить и поставить варить. Когда крупа разварится, опустить в суп промытые целые грибы. На растительном масле поджарить мелко нарезанный лук, заправить его 1 столовой ложкой муки и добавить в суп. Как только грибы станут мягкими, их нужно мелко порубить, разложить в тарелки, залить бульоном и подать к столу. Пропорция: 500 г шампиньонов, 2-3 столовые ложки перловой крупы, 4-5 шт. картофеля, 2-3 луковицы, 2 моркови, по 1 корню петрушки и сельдерея, 2-3 столовые ложки подсолнечного масла, 1 столовая ложка муки.
Брюссельский суп из шампиньонов.
Грибы очистить, промыть, пропустить через мясорубку и потушить в масле вместе с натертым луком в течение 10 мин на медленном огне. Добавить муку, влить бульон и приправить его. Суп снять с огня, добавить сливки, посыпать зеленью петрушки и крупно нарубленными яйцами.
Пропорция: 500 г шампиньонов, 2 столовые ложки масла, 1 луковица, 1 столовая ложка муки, 1 л бульона из костей, соль, перец, 1 стакан сливок, 2 сваренных вкрутую яйца, 1 столовая ложка мелко нарубленной зелени петрушки.
Вторые блюда из грибов
Картофельные зразы с грибами. Отварные сухие или свежие грибы смешать с мелко нарезанным жареным луком и слегка поджарить, посолить, поперчить. Разделать картофельное пюре в виде лепешек. Положить на середину каждой лепешки начинку, соединить края, придать форму пирожка, смазать яйцом, обвалять в сухарях. Обжарить, выложить на блюдо, полить сверху маслом со сковороды. Пропорция: 1 кг картофеля, 100-125 г сухих или 200-250 г свежих грибов, 2 луковицы, 2-3 столовые ложки масла, 100 г сметаны, соль, перец, яичный желток. Тушеные грибы
Грибы в сметане (старинное русское блюдо).
Очищенные и промытые в холодной воде грибы ошпарить кипятком, откинуть на сито,, чтобы стекла вода, нарезать ломтиками, посолить, выложить на сковороду и поджарить. Растереть муку с маслом, развести сметаной и перед окончанием жарения добавить в грибы и дать прокипеть. Подать к столу, посыпав измельченной зеленью петрушки и укропа. Если для этого блюда используются сморчки, их до обжаривания 5 мин варят, залив кипятком, а затем промывают в холодной воде.
Пропорция: 500 г свежих грибов, 100 г сметаны, 2столовые ложки масла, 0,5 столовой ложки муки, соль, петрушка, укроп.
Гречневая каша с грибами (старинное русское блюдо).
Сварить грибной бульон. Вынуть грибы, промыть холодной водой, нарезать и поджарить. Отдельно поджарить лук. Подготовленную крупу обжарить, посолить, залить горячим грибным бульоном. Сварить рассыпчатую кашу и перед подачей на стол смешать ее с грибами и луком.
Пропорция: 2,5 стакана гречневой крупы, 3-3,5 стакана грибного бульона, 2 столовые ложки масла, 75 г сухих грибов или 150 г свежих, соль, лук репчатый.
Грибная запеканка (финское блюдо).
Нарезать грибы и лук (при желании его можно подрумянить). В охлажденную массу добавить молоко, панировочные сухари, сырые яйца, и размешать до средней густоты. Массу уложить в форму, поместить в духовку примерно на 1 ч. Блюдо подать к столу с подливкой из томатов или с растопленным маслом.
Пропорция: 1 кг свежих или 0,5 кг соленых грибов, 2-3 луковицы, 2 яйца, 0,4 л снятого молока, 100-200 г панировочных сухарей, 2-4 столовые ложки сливочного масла, соль.
Шампиньоны провансаль (французское блюдо).
Очищенные молодые грибы разрезать пополам, промыть в теплой воде, обсушить и залить на 2 ч растительным маслом с перцем и растертой долькой чеснока. Затем в этом же масле тушить их до готовности. В готовые грибы добавить петрушку и немного лимонного сока. Подают это блюдо с гренками.
Котлеты из шампиньонов (старинное русское блюдо).
Очищенные и вымытые грибы (800 г) мелко порубить, положить в сотейник с жиром и поставить тушить (выделившийся из грибов сок упаривают наполовину). Затем всыпать 3 столовые ложки манной крупы и варить 5-10 мин на слабом огне. Три большие луковицы нарезать мелкими кубиками, поджарить в русском масле и добавить к грибам, соль и перец положить по вкусу. Полученную массу в горячем состоянии разделать на котлеты, обвалять в сухарях и жарить на сковороде до образования румяной корочки после чего на 5-10 мин поставить в духовой шкаф. На стол котлеты подают в сметанном соусе (к приготовленному белому соусу добавляют сметану и прогревают 2-3 мин на слабом огне).
Кольцевики или подосиновики, тушенные в остром соусе.
Грибы очистить, промыть, нарезать ломтиками и тушить до момента выделения сока. Муку и мелко нарезанный лук подрумянить в кастрюле на разогретом масле, добавить овощной отвар, горчицу, лимонный сок, соль, перец, щепотку сахара и тушить грибы до готовности.
Пропорция: 700 г грибов, 1 стакан овощного отвара, 40 г муки, 2 столовые ложки масла, 1 крупная луковица, соль, перец, лимонный сок.
Шампиньоны фаршированные (французкое блюдо).
У грибов удалить ножки, а шляпки заполнить растертым в сметане печеночным паштетом и на 10-15 мин поместить в духовку. Перед подачей на стол украсить петрушкой.
Грибная запеканка с яйцом (финское блюдо).
Нарезать грифы и сосиски кубиками 1 х 1 см и заложить все в смазанную маслом форму. Массу залить подсоленным молоком со взбитыми яйцами и горчицей. Сверху присыпать слоем тертого сыра и форму поместить на 45 минут в духовку при температуре 175°С. Запеканка подается к столу как основное блюдо с отварным картофелем и растопленным сливочным маслом.
Пропорция: грибы — 750 г, сосиски — 8 шт., яйца — 3 шт., молоко — 0,6 л, 1 столовая ложка горчицы, сыр тертый, соль.
Шампиньоны в булке (французское блюдо).
Сначала делают соус: в кастрюльке распускают 50 г масла, в нем поджаривают две мелко нарезанные луковицы, добавляют соль, перец и все разводят, быстро помешивая, стаканом горячего бульона. Затем ставят на слабый огонь и дают бульону наполовину выкипеть. Отдельно отваривают в воде с маслом 300 г шампиньонов, туда же вливают готовый соус и дают немного покипеть на слабом огне. Затем берут круглую булку, срезают нижнюю корку, вынимают мякиш, чтобы образовалось углубление. Булку подсушивают, смазывают маслом и кладут на блюде углублением вверх. К грибам добавляют два желтка, немного сливок, лимонного сока и масла. Все перемешивают, быстро выкладывают в булку и тут же подают к столу.
Грибы, запеченные в сметане с сыром (старинное русское блюдо).
Очищенные и тщательно промытые молодые грибы кладут на 5-6 мин в кипящую воду, затем воду сливают, грибы разрезают на мелкие кусочки и жарят в масле 10-15 мин. Потом добавляют в грибы муку, сметану и кипятят 3-5 мин. Сваренные грибы кладут в глубокую сковороду или другую посуду, густо посыпают сверху тертым сыром и запекают в духовке. К столу подают с укропом.
Пропорция: 1 кг свежих грибов (белых, подберезовиков, подосиновиков и др.), 40 г сливочного масла, 30 г сыра, 1 стакан сметаны, 1 столовая ложка муки, укроп, соль.
"Рагу лесоруба" (финское блюдо).
Вскипятить в кастрюле 0,5 л воды и растворить в ней кубик мясного бульона. В кипящий бульон мелкими ломтиками нарезать картофель, морковь и цветную капусту. Дать овощам провариться 5 мин, после чего добавить горох и немного томатной пасты. Плотно прикрыть кастрюлю крышкой и довести овощи до готовности. Нарезанные грибы и лук колечками подрумянивают на жире и добавляют молоко. Плавленый сыр небольшими кусочками добавляют в кипящий молочный бульон, после чего его довольно щедро приправляют специями. Осторожно помешивая овощи, в кастрюлю вливают молочный бульон. Сверху рагу украшают ломтиками помидоров, посыпают петрушкой и подают в горячем виде.
Пропорция: 500 г трубчатых грибов (их можно заменить лисичками или другими грибами), 3-4 картофелины, 3 моркови, 1 небольшой кочан цветной капусты, горох, кубик мясного бульона, 1 лук-порей, 0,1 л молока, 100 г плавленого сыра, помидоры, соль, перец, петрушка.
Свежие грибы с рисом (болгарское блюдо).
Поджарить в 3/4 чайного стакан а жира 1-2 головки лука. Когда лук станет мягким, его смешивают с 1 кг свежих очищенных, вымытых и нарезанных не особенно крупными кусками грибов. К размягченным грибам, добавляют 2-3 нарезанных помидора,соль, черный перец и стакан риса, вливают 3 половника горячей воды и варят на слабом огне в течение 20-30 мин. Готовое блюдо посыпают зеленью петрушки.
Рыбно-грибная запеканка (финское блюдо).
Рыбное филе натереть лимоном, посолить и выложить в смазанную маслом жаростойкую форму. Вычищенные грибы с небольшим количеством лука обжарить в масле и поперчить. На филе положить слоями нарезанные ломтикам помидоры, грибы и мелко нарубленную петрушку, добавить воду и сметану. Запеканку тушить в духовке при температуре 200°С, перед подачей на стол посыпать тертым сыром.
Пропорция: 0,5 кг рыбного филе, 1 кг лисичек или других мелких грибов, 3 шт. помидоров, 1 головка лука репчатого, сливочное масло, перец, лимон, петрушка, сыр.
Тушеные грибы (болгарское блюдо).
750 г свежих или консервированных грибов очистить, вымыть и нарезать, положить в кастрюлю и тушить, положив 3 столовые ложки масла. Когда они станут мягкими, добавить 1/2 стакана белого вина, чайную ложку черного перца и пучок мелко нарезанной петрушки. При подаче на стол грибы приправляют лимонным соком.
Грибы маринованные (болгарское блюдо).
Очистить и нарезать маленькими кубиками 1-2 головки лука, морковь и полкорня сельдерея. Тушить коренья надо в 150 г растительного или 120 г сливочного масла. К тушеным кореньям добавить 500-750 г свежих грибов, предварительно очищенных, вымытых и не очень мелко нарезанных. Когда грибы размягчатся, добавить 2-3 мелко нарезанных помидора, по чайной ложке муки и черного перца, соль и 1/2 стакана вина. Содержимое залить горячей водой, слегка покрыв грибы, и варить на слабом огне. Готовое блюдо приправляют толченым чесноком.
Телятина, тушенная с грибами и ветчиной (болгарское блюдо).
1250 г телятины очистить от сухожилий и пленок и жарить в 1/2 стакана разогретого жира до тех пор, пока не зарумянится со всех сторон. Затем вынуть мясо, а в жире зажарить до мягкости 3-4 мелко нарезанных головки лука, 2-5 ломтиков ветчины, нарезанной продолговатыми кусочками, и около 300 г грибов, нарезанных полосками. После того, как грибы будут готовы, прибавить столовую ложку томата-пюре, заправить мукой, залить горячей водой или бульоном, чтобы получился не очень густой соус, добавить в него соль по вкусу и 8-10 горошин черного перца. Затем положить в соус мясо и доварить его на слабом огне в плотно закрытой кастрюле. Перед подачей на стол мясо нарезать на тонкие ломтики и залить соусом, не протирая его. На гарнир можно подать картофель-соте.
Плакия из свежих грибов (болгарское блюдо).
Нарезать кубиками 2-3 моркови, корень сельдерея, 5-6 головок лука, 1/2 головки чеснока и поставить тушить в 75 г жира и таком же количестве воды. Когда овощи станут мягкими, к ним добавить 1 кг свежих очищенных и обмытых грибов; если грибы крупные, надо нарезать их ломтиками. Тушат грибы на умеренном огне в плотно закрытой кастрюле, время от времени помешивая, чтобы не подгорели. Когда они станут мягкими, их выкладывают на противень, заливают стаканом горячей воды и прибавляют 4-5 нарезанных помидоров. Затем толкут 5-6 долек чеснока, смешивают с уксусом, заливают этой смесью грибы и добавляют столовую ложку муки, разведенной холодной водой. Сверху посыпают петрушкой, кладут ломтики, добавляют 75 г растительного масла и запекают в духовке примерно полчаса (можно и варить на слабом огне).
Шпинат с грибами (румынское блюдо).
Шпинат перебрать, вымыть в нескольких водах, ошпарить крутым соленым кипятком, отжать и положить в неглубокую кастрюлю, прибавив 1 столовую ложку сливочного масла. Предварительно очищенные и нарезанные ломтиками грибы поставить тушить отдельно с маслом, затем перемешать шпинат с грибами, прибавить тертый сыр и 1 столовую ложку масла, уложить в глиняную форму, поставить в духовку, посыпав тертым сыром и положив сверху немного масла. Держать несколько минут, пока не подрумянится.
Пропорция: 1 кг шпината, 150 г грибов, 3 столовые ложки сливочного масла, 2 столовые ложки сыра, соль.
Цветная капуста с грибами в духовке (румынское блюдо).
Выбрать цветную капусту без изъяна, отварить в соленом кипятке и разобрать на части. Очистить одновременно с этим грибы, нарезать тонкими ломтиками и поставить тушить в небольшом количестве масла. Приготовить отдельно соус из 1 столовой ложки масла и 2 столовых ложек муки, разбавить его двумя стаканами молока или воды, в которой варилась цветная капуста. Когда соус сварится до нужной густоты, вбить в него 1 желток с несколькими каплями лимонного сока и посолить. Смазать маслом глиняную форму, уложить на дно равномерным слоем часть цветной капусты, положить поверх ряд грибов и прикрыть оставшейся капустой. Полить соусом, посыпать мелко натертым сыром, положить сверху несколько кусочков масла и поставить в духовой шкаф. Держать, пока не подрумянится. Подавать к столу в форме.
Пропорция: 1 большой кочан цветной капусты, 200 г грибов, по 2 столовые ложки муки и сливочного масла, 1 1/2 стакана молока, 1 желток, 1 чайная ложка сливочного масла, 1 столовая ложка тертого сыра, соль.
Грибное рагу (румынское блюдо).
Очистить грибы, отломив ножки, большие грибы разрезать на несколько частей. Нарезанный лук слегка поджарить в ложке масла, смешать с грибами и держать на огне, пока из них не испарится вся влага. Прибавить муку, несколько помидоров (предварительно сняв кожицу и вынув семена), соль, немного нарезанной зелени. Держать на огне под крышкой, пока рагу не стушится. Подавать очень горячим.
Пропорция: 1 кг грибов, 2 луковицы, 4 помидора, 2 столовые ложки сливочного масла, 1 чайная ложка муки, соль, перец, зелень.
Плов с сушеными грибами (румынское блюдо).
Замочить накануне грибы. Поджарить в растительном масле 2 мелко нарезанные луковицы. Перебрать и промыть рис, высушить на полотенце, смешать с луком, не убирая с огня. Когда рис и лук начнут розоветь, переложить их в неглубокую кастрюлю, прибавив 150 г предварительно отваренных и мелко нарезанных грибов. Затем влить туда 3 стакана воды, в которой замачивались и варились грибы (отвар нужно предварительно процедить), прибавить соль, перец, ложку томата-пюре, поставить в духовку и держать в ней, пока рис не сварится. Подают блюдо к столу холодным. Можно готовить плов и со свежими грибами; по желанию его подают к столу горячим со сметанным соусом.
Пропорция: 150 г сушеных белых грибов или 300 г свежих, 1 1/2 стакана риса, 2 луковицы, 3 столовые ложки растительного масла, 1 столовая ложка томата-пюре, соль, перец.
Рыжики, жаренные со сметаной (старинное русское блюдо).
Очистить от земли и тщательно промыть 0,5 кг грибов, откинуть их на решето, дать стечь воде и жарить в масле. Потушить в масле мелко нарезанную луковицу. Затем грибы положить в тушеный лук и продолжать тушить все вместе 40-50 мин. После этого добавить в грибы 1/4 стакана сметаны и кипятить 10-15 мин. К столу грибы подают, посыпав их перцем и укропом.
Боровички, жаренные с луковой подливой (старинное русское блюдо).
Свежие молодые грибы (шляпки, 1 кг) вымыть, обсушить, посолить и жарить 15 мин на сковороде в сильно разогретом масле, часто помешивая, а затем снять и поставить в теплое место. В разогретое масло положить нашинкованный лук (20 г), посолить и тушить до мягкости, после чего добавить стакан сметаны, вскипятить и полученной подливой залить грибы.
Грибы, тушенные в сливках (старинное русское блюдо).
Свежие грибы (белые, подберезовики, подосиновики) очистить, промыть, ошпарить, нарезать дольками, посолить и слегка обжарить. Сложить их в горшок или кастрюлю и залить кипячеными сливками. Зелень петрушки и укропа связать, вложив в середину пучка корицу, перец, лавровый лист, положить в грибы, посолить и, накрыв крышкой, поставить в умеренно горячую духовку на 1 ч. Когда грибы будут готовы, зелень вынуть, а грибы подать в той же посуде, в которой они тушились.
Пропорция: 500 г грибов, 1 стакан сливок, 1 столовая ложка масла.
Шампиньоны фаршированные (итальянское блюдо).
Грибы очистить и вымыть. Шляпки (целые) и мелко изрубленные ножки отдельно потушить в масле. Затем тушеные ножки смешать с картофельным пюре, хорошо поперчить и этой смесью наполнить шляпки. На каждую шляпку положить по ломтику огурца.
Пропорция: 300 г шампиньонов, 1 столовая ложка масла, 1 стакан картофельного пюре, 1 небольшой соленый огурец, соль, перец.
Скумбрия в соусе из шампиньонов (французское блюдо).
Рыбу очистить, посолить, сбрызнуть лимонным соком, обжарить в масле с обеих сторон, положить в предварительно подогретую посуду и поставить в теплое место. В оставшееся от жарения масло добавить муку, тертый сыр и немного воды. Приготовленную подливу приправить солью, перцем и соком лимона, добавить желток и белое вино, все хорошо перемешать. Рыбу залить приправленным соусом и подавать с тушенными в масле шампиньонами.
Пропорция: 2 скумбрии, 1 столовая ложка муки, по 1-2 столовые ложки сливочного масла или маргарина и тертого сыра, 1 ликерная рюмка белого вина, 1-2 столовые ложки сливок, соль, перец, сок лимона, 1 желток, 150 г шампиньонов.
Котлеты из грибов (старинное русское блюдо).
Сушеные белые грибы (100 г) сварить в воде и мелко изрубить. Отдельно сварить в воде рис (1 стакан), прибавив соль и петрушку, откинуть на решето, смешать с грибами, всыпать мускатный орех, сделать котлеты, посыпать их мукой или окунуть в кляр, пожарить на масле и подавать с зеленым горошком.
Котлеты из грибов (старинное русское блюдо).
Свежие белые грибы (400 г) обварить кипятком, обсушить полотенцем, очень мелко изрубить, прибавить 1 1/2 стакана сливок, 50 г сливочного масла, 4 яйца, немного перца, мускатного ореха, 6 мелко нарезанных килек и 2 испеченные луковицы. Все это смешать с таким количеством сухого натертого на терке белого хлеба, чтобы из массы можно было сделать котлеты. Дать массе постоять 30 мин, чтобы хлеб разбух. Сделать котлеты и поджарить их в масле. Подавать к столу горячими.
Зонтики жареные (чешское блюдо).
Шляпки зонтика пестрого или белого промыть, посолить, обвалять в панировочных сухарях или яйце и обжарить в расплавленном жире. Подавать целыми, горячими, посыпав мелко нарезанной зеленью петрушки и укропа.
Тушеные грибы
Грибы в сметане (старинное русское блюдо).
Очищенные и промытые в холодной воде грибы ошпарить кипятком, откинуть на сито,, чтобы стекла вода, нарезать ломтиками, посолить, выложить на сковороду и поджарить. Растереть муку с маслом, развести сметаной и перед окончанием жарения добавить в грибы и дать прокипеть. Подать к столу, посыпав измельченной зеленью петрушки и укропа. Если для этого блюда используются сморчки, их до обжаривания 5 мин варят, залив кипятком, а затем промывают в холодной воде.
Пропорция: 500 г свежих грибов, 100 г сметаны, 2столовые ложки масла, 0,5 столовой ложки муки, соль, петрушка, укроп.
Гречневая каша с грибами (старинное русское блюдо).
Сварить грибной бульон. Вынуть грибы, промыть холодной водой, нарезать и поджарить. Отдельно поджарить лук. Подготовленную крупу обжарить, посолить, залить горячим грибным бульоном. Сварить рассыпчатую кашу и перед подачей на стол смешать ее с грибами и луком.
Пропорция: 2,5 стакана гречневой крупы, 3-3,5 стакана грибного бульона, 2 столовые ложки масла, 75 г сухих грибов или 150 г свежих, соль, лук репчатый.
Грибная запеканка (финское блюдо).
Нарезать грибы и лук (при желании его можно подрумянить). В охлажденную массу добавить молоко, панировочные сухари, сырые яйца, и размешать до средней густоты. Массу уложить в форму, поместить в духовку примерно на 1 ч. Блюдо подать к столу с подливкой из томатов или с растопленным маслом.
Пропорция: 1 кг свежих или 0,5 кг соленых грибов, 2-3 луковицы, 2 яйца, 0,4 л снятого молока, 100-200 г панировочных сухарей, 2-4 столовые ложки сливочного масла, соль.
Шампиньоны провансаль (французское блюдо).
Очищенные молодые грибы разрезать пополам, промыть в теплой воде, обсушить и залить на 2 ч растительным маслом с перцем и растертой долькой чеснока. Затем в этом же масле тушить их до готовности. В готовые грибы добавить петрушку и немного лимонного сока. Подают это блюдо с гренками.
Котлеты из шампиньонов (старинное русское блюдо).
Очищенные и вымытые грибы (800 г) мелко порубить, положить в сотейник с жиром и поставить тушить (выделившийся из грибов сок упаривают наполовину). Затем всыпать 3 столовые ложки манной крупы и варить 5-10 мин на слабом огне. Три большие луковицы нарезать мелкими кубиками, поджарить в русском масле и добавить к грибам, соль и перец положить по вкусу. Полученную массу в горячем состоянии разделать на котлеты, обвалять в сухарях и жарить на сковороде до образования румяной корочки после чего на 5-10 мин поставить в духовой шкаф. На стол котлеты подают в сметанном соусе (к приготовленному белому соусу добавляют сметану и прогревают 2-3 мин на слабом огне).
Кольцевики или подосиновики, тушенные в остром соусе.
Грибы очистить, промыть, нарезать ломтиками и тушить до момента выделения сока. Муку и мелко нарезанный лук подрумянить в кастрюле на разогретом масле, добавить овощной отвар, горчицу, лимонный сок, соль, перец, щепотку сахара и тушить грибы до готовности.
Пропорция: 700 г грибов, 1 стакан овощного отвара, 40 г муки, 2 столовые ложки масла, 1 крупная луковица, соль, перец, лимонный сок.
Шампиньоны фаршированные (французкое блюдо).
У грибов удалить ножки, а шляпки заполнить растертым в сметане печеночным паштетом и на 10-15 мин поместить в духовку. Перед подачей на стол украсить петрушкой.
Грибная запеканка с яйцом (финское блюдо).
Нарезать грифы и сосиски кубиками 1 х 1 см и заложить все в смазанную маслом форму. Массу залить подсоленным молоком со взбитыми яйцами и горчицей. Сверху присыпать слоем тертого сыра и форму поместить на 45 минут в духовку при температуре 175°С. Запеканка подается к столу как основное блюдо с отварным картофелем и растопленным сливочным маслом.
Пропорция: грибы — 750 г, сосиски — 8 шт., яйца — 3 шт., молоко — 0,6 л, 1 столовая ложка горчицы, сыр тертый, соль.
Шампиньоны в булке (французское блюдо).
Сначала делают соус: в кастрюльке распускают 50 г масла, в нем поджаривают две мелко нарезанные луковицы, добавляют соль, перец и все разводят, быстро помешивая, стаканом горячего бульона. Затем ставят на слабый огонь и дают бульону наполовину выкипеть. Отдельно отваривают в воде с маслом 300 г шампиньонов, туда же вливают готовый соус и дают немного покипеть на слабом огне. Затем берут круглую булку, срезают нижнюю корку, вынимают мякиш, чтобы образовалось углубление. Булку подсушивают, смазывают маслом и кладут на блюде углублением вверх. К грибам добавляют два желтка, немного сливок, лимонного сока и масла. Все перемешивают, быстро выкладывают в булку и тут же подают к столу.
Грибы, запеченные в сметане с сыром (старинное русское блюдо).
Очищенные и тщательно промытые молодые грибы кладут на 5-6 мин в кипящую воду, затем воду сливают, грибы разрезают на мелкие кусочки и жарят в масле 10-15 мин. Потом добавляют в грибы муку, сметану и кипятят 3-5 мин. Сваренные грибы кладут в глубокую сковороду или другую посуду, густо посыпают сверху тертым сыром и запекают в духовке. К столу подают с укропом.
Пропорция: 1 кг свежих грибов (белых, подберезовиков, подосиновиков и др.), 40 г сливочного масла, 30 г сыра, 1 стакан сметаны, 1 столовая ложка муки, укроп, соль.
"Рагу лесоруба" (финское блюдо).
Вскипятить в кастрюле 0,5 л воды и растворить в ней кубик мясного бульона. В кипящий бульон мелкими ломтиками нарезать картофель, морковь и цветную капусту. Дать овощам провариться 5 мин, после чего добавить горох и немного томатной пасты. Плотно прикрыть кастрюлю крышкой и довести овощи до готовности. Нарезанные грибы и лук колечками подрумянивают на жире и добавляют молоко. Плавленый сыр небольшими кусочками добавляют в кипящий молочный бульон, после чего его довольно щедро приправляют специями. Осторожно помешивая овощи, в кастрюлю вливают молочный бульон. Сверху рагу украшают ломтиками помидоров, посыпают петрушкой и подают в горячем виде.
Пропорция: 500 г трубчатых грибов (их можно заменить лисичками или другими грибами), 3-4 картофелины, 3 моркови, 1 небольшой кочан цветной капусты, горох, кубик мясного бульона, 1 лук-порей, 0,1 л молока, 100 г плавленого сыра, помидоры, соль, перец, петрушка.
Свежие грибы с рисом (болгарское блюдо).
Поджарить в 3/4 чайного стакан а жира 1-2 головки лука. Когда лук станет мягким, его смешивают с 1 кг свежих очищенных, вымытых и нарезанных не особенно крупными кусками грибов. К размягченным грибам, добавляют 2-3 нарезанных помидора,соль, черный перец и стакан риса, вливают 3 половника горячей воды и варят на слабом огне в течение 20-30 мин. Готовое блюдо посыпают зеленью петрушки.
Рыбно-грибная запеканка (финское блюдо).
Рыбное филе натереть лимоном, посолить и выложить в смазанную маслом жаростойкую форму. Вычищенные грибы с небольшим количеством лука обжарить в масле и поперчить. На филе положить слоями нарезанные ломтикам помидоры, грибы и мелко нарубленную петрушку, добавить воду и сметану. Запеканку тушить в духовке при температуре 200°С, перед подачей на стол посыпать тертым сыром.
Пропорция: 0,5 кг рыбного филе, 1 кг лисичек или других мелких грибов, 3 шт. помидоров, 1 головка лука репчатого, сливочное масло, перец, лимон, петрушка, сыр.
Тушеные грибы (болгарское блюдо).
750 г свежих или консервированных грибов очистить, вымыть и нарезать, положить в кастрюлю и тушить, положив 3 столовые ложки масла. Когда они станут мягкими, добавить 1/2 стакана белого вина, чайную ложку черного перца и пучок мелко нарезанной петрушки. При подаче на стол грибы приправляют лимонным соком.
Грибы маринованные (болгарское блюдо).
Очистить и нарезать маленькими кубиками 1-2 головки лука, морковь и полкорня сельдерея. Тушить коренья надо в 150 г растительного или 120 г сливочного масла. К тушеным кореньям добавить 500-750 г свежих грибов, предварительно очищенных, вымытых и не очень мелко нарезанных. Когда грибы размягчатся, добавить 2-3 мелко нарезанных помидора, по чайной ложке муки и черного перца, соль и 1/2 стакана вина. Содержимое залить горячей водой, слегка покрыв грибы, и варить на слабом огне. Готовое блюдо приправляют толченым чесноком.
Телятина, тушенная с грибами и ветчиной (болгарское блюдо).
1250 г телятины очистить от сухожилий и пленок и жарить в 1/2 стакана разогретого жира до тех пор, пока не зарумянится со всех сторон. Затем вынуть мясо, а в жире зажарить до мягкости 3-4 мелко нарезанных головки лука, 2-5 ломтиков ветчины, нарезанной продолговатыми кусочками, и около 300 г грибов, нарезанных полосками. После того, как грибы будут готовы, прибавить столовую ложку томата-пюре, заправить мукой, залить горячей водой или бульоном, чтобы получился не очень густой соус, добавить в него соль по вкусу и 8-10 горошин черного перца. Затем положить в соус мясо и доварить его на слабом огне в плотно закрытой кастрюле. Перед подачей на стол мясо нарезать на тонкие ломтики и залить соусом, не протирая его. На гарнир можно подать картофель-соте.
Плакия из свежих грибов (болгарское блюдо).
Нарезать кубиками 2-3 моркови, корень сельдерея, 5-6 головок лука, 1/2 головки чеснока и поставить тушить в 75 г жира и таком же количестве воды. Когда овощи станут мягкими, к ним добавить 1 кг свежих очищенных и обмытых грибов; если грибы крупные, надо нарезать их ломтиками. Тушат грибы на умеренном огне в плотно закрытой кастрюле, время от времени помешивая, чтобы не подгорели. Когда они станут мягкими, их выкладывают на противень, заливают стаканом горячей воды и прибавляют 4-5 нарезанных помидоров. Затем толкут 5-6 долек чеснока, смешивают с уксусом, заливают этой смесью грибы и добавляют столовую ложку муки, разведенной холодной водой. Сверху посыпают петрушкой, кладут ломтики, добавляют 75 г растительного масла и запекают в духовке примерно полчаса (можно и варить на слабом огне).
Шпинат с грибами (румынское блюдо).
Шпинат перебрать, вымыть в нескольких водах, ошпарить крутым соленым кипятком, отжать и положить в неглубокую кастрюлю, прибавив 1 столовую ложку сливочного масла. Предварительно очищенные и нарезанные ломтиками грибы поставить тушить отдельно с маслом, затем перемешать шпинат с грибами, прибавить тертый сыр и 1 столовую ложку масла, уложить в глиняную форму, поставить в духовку, посыпав тертым сыром и положив сверху немного масла. Держать несколько минут, пока не подрумянится.
Пропорция: 1 кг шпината, 150 г грибов, 3 столовые ложки сливочного масла, 2 столовые ложки сыра, соль.
Цветная капуста с грибами в духовке (румынское блюдо).
Выбрать цветную капусту без изъяна, отварить в соленом кипятке и разобрать на части. Очистить одновременно с этим грибы, нарезать тонкими ломтиками и поставить тушить в небольшом количестве масла. Приготовить отдельно соус из 1 столовой ложки масла и 2 столовых ложек муки, разбавить его двумя стаканами молока или воды, в которой варилась цветная капуста. Когда соус сварится до нужной густоты, вбить в него 1 желток с несколькими каплями лимонного сока и посолить. Смазать маслом глиняную форму, уложить на дно равномерным слоем часть цветной капусты, положить поверх ряд грибов и прикрыть оставшейся капустой. Полить соусом, посыпать мелко натертым сыром, положить сверху несколько кусочков масла и поставить в духовой шкаф. Держать, пока не подрумянится. Подавать к столу в форме.
Пропорция: 1 большой кочан цветной капусты, 200 г грибов, по 2 столовые ложки муки и сливочного масла, 1 1/2 стакана молока, 1 желток, 1 чайная ложка сливочного масла, 1 столовая ложка тертого сыра, соль.
Грибное рагу (румынское блюдо).
Очистить грибы, отломив ножки, большие грибы разрезать на несколько частей. Нарезанный лук слегка поджарить в ложке масла, смешать с грибами и держать на огне, пока из них не испарится вся влага. Прибавить муку, несколько помидоров (предварительно сняв кожицу и вынув семена), соль, немного нарезанной зелени. Держать на огне под крышкой, пока рагу не стушится. Подавать очень горячим.
Пропорция: 1 кг грибов, 2 луковицы, 4 помидора, 2 столовые ложки сливочного масла, 1 чайная ложка муки, соль, перец, зелень.
Плов с сушеными грибами (румынское блюдо).
Замочить накануне грибы. Поджарить в растительном масле 2 мелко нарезанные луковицы. Перебрать и промыть рис, высушить на полотенце, смешать с луком, не убирая с огня. Когда рис и лук начнут розоветь, переложить их в неглубокую кастрюлю, прибавив 150 г предварительно отваренных и мелко нарезанных грибов. Затем влить туда 3 стакана воды, в которой замачивались и варились грибы (отвар нужно предварительно процедить), прибавить соль, перец, ложку томата-пюре, поставить в духовку и держать в ней, пока рис не сварится. Подают блюдо к столу холодным. Можно готовить плов и со свежими грибами; по желанию его подают к столу горячим со сметанным соусом.
Пропорция: 150 г сушеных белых грибов или 300 г свежих, 1 1/2 стакана риса, 2 луковицы, 3 столовые ложки растительного масла, 1 столовая ложка томата-пюре, соль, перец.
Рыжики, жаренные со сметаной (старинное русское блюдо).
Очистить от земли и тщательно промыть 0,5 кг грибов, откинуть их на решето, дать стечь воде и жарить в масле. Потушить в масле мелко нарезанную луковицу. Затем грибы положить в тушеный лук и продолжать тушить все вместе 40-50 мин. После этого добавить в грибы 1/4 стакана сметаны и кипятить 10-15 мин. К столу грибы подают, посыпав их перцем и укропом.
Боровички, жаренные с луковой подливой (старинное русское блюдо).
Свежие молодые грибы (шляпки, 1 кг) вымыть, обсушить, посолить и жарить 15 мин на сковороде в сильно разогретом масле, часто помешивая, а затем снять и поставить в теплое место. В разогретое масло положить нашинкованный лук (20 г), посолить и тушить до мягкости, после чего добавить стакан сметаны, вскипятить и полученной подливой залить грибы.
Грибы, тушенные в сливках (старинное русское блюдо).
Свежие грибы (белые, подберезовики, подосиновики) очистить, промыть, ошпарить, нарезать дольками, посолить и слегка обжарить. Сложить их в горшок или кастрюлю и залить кипячеными сливками. Зелень петрушки и укропа связать, вложив в середину пучка корицу, перец, лавровый лист, положить в грибы, посолить и, накрыв крышкой, поставить в умеренно горячую духовку на 1 ч. Когда грибы будут готовы, зелень вынуть, а грибы подать в той же посуде, в которой они тушились.
Пропорция: 500 г грибов, 1 стакан сливок, 1 столовая ложка масла.
Шампиньоны фаршированные (итальянское блюдо).
Грибы очистить и вымыть. Шляпки (целые) и мелко изрубленные ножки отдельно потушить в масле. Затем тушеные ножки смешать с картофельным пюре, хорошо поперчить и этой смесью наполнить шляпки. На каждую шляпку положить по ломтику огурца.
Пропорция: 300 г шампиньонов, 1 столовая ложка масла, 1 стакан картофельного пюре, 1 небольшой соленый огурец, соль, перец.
Скумбрия в соусе из шампиньонов (французское блюдо).
Рыбу очистить, посолить, сбрызнуть лимонным соком, обжарить в масле с обеих сторон, положить в предварительно подогретую посуду и поставить в теплое место. В оставшееся от жарения масло добавить муку, тертый сыр и немного воды. Приготовленную подливу приправить солью, перцем и соком лимона, добавить желток и белое вино, все хорошо перемешать. Рыбу залить приправленным соусом и подавать с тушенными в масле шампиньонами.
Пропорция: 2 скумбрии, 1 столовая ложка муки, по 1-2 столовые ложки сливочного масла или маргарина и тертого сыра, 1 ликерная рюмка белого вина, 1-2 столовые ложки сливок, соль, перец, сок лимона, 1 желток, 150 г шампиньонов.
Котлеты из грибов (старинное русское блюдо).
Сушеные белые грибы (100 г) сварить в воде и мелко изрубить. Отдельно сварить в воде рис (1 стакан), прибавив соль и петрушку, откинуть на решето, смешать с грибами, всыпать мускатный орех, сделать котлеты, посыпать их мукой или окунуть в кляр, пожарить на масле и подавать с зеленым горошком.
Котлеты из грибов (старинное русское блюдо).
Свежие белые грибы (400 г) обварить кипятком, обсушить полотенцем, очень мелко изрубить, прибавить 1 1/2 стакана сливок, 50 г сливочного масла, 4 яйца, немного перца, мускатного ореха, 6 мелко нарезанных килек и 2 испеченные луковицы. Все это смешать с таким количеством сухого натертого на терке белого хлеба, чтобы из массы можно было сделать котлеты. Дать массе постоять 30 мин, чтобы хлеб разбух. Сделать котлеты и поджарить их в масле. Подавать к столу горячими.
Зонтики жареные (чешское блюдо).
Шляпки зонтика пестрого или белого промыть, посолить, обвалять в панировочных сухарях или яйце и обжарить в расплавленном жире. Подавать целыми, горячими, посыпав мелко нарезанной зеленью петрушки и укропа.
Грибные салаты, соусы, начинки, пироги
 Прежде чем обрабатывать грибы, их необходимо тщательно рассортировать по видам
Салат с вешенкой обыкновенной и картофелем.
Для него необходимы 300 г соленых, маринованных или обжаренных плодовых тел вешенки обыкновенной, 200 г отварного картофеля, 1 огурец, 1 луковица, 200-300 г сметаны, соль, сахар, горчица. Продукты нарезают красивыми ровными дольками и смешивают с заправленной сметаной.
Салат из грибов (болгарское блюдо).
0,5 кг грибов хорошо вымыть и прокипятить в соленой воде 10-15 мин вместе с несколькими зернышками черного перца и 2-3 лавровыми листьями. Затем грибы откинуть на сито, дать стечь отвару, нарезать и положить в маринад, приготовленный из неполной кофейной чашки уксуса, небольшого количества соли, кофейной чашки растительного масла, 5-6 долек измельченного чеснока и пучка мелко нарезанной петрушки. Смесь слегка размешать и через 10-15 мин подать к столу.
Салат из грибов и яиц (старинное русское блюдо).
Около 1 кг грибов чистят, хорошо промывают, варят в подсоленной воде и откидывают на сито, чтобы стекла вода. Растирают с черным перцем 5 сваренных вкрутую желтков, добавляют 80 г растительного масла, сок целого лимона или 1/2 стакана уксуса, все размешивают и заливают этой смесью грибы, слегка помешивая. Готовое блюдо перед подачей на стол посыпают петрушкой.
Грибной салат с ветчиной (финское блюдо).
Для него берут 200 г соленых, маринованных или отварных грибов, 200 г ветчины, 200 г отварного картофеля, 1 соленый огурец и 1 луковицу, 200-300 г сметаны, столовый уксус, соль, сахар, горчицу. Продукты нарезают ровными дольками и смешивают с заправленной сметаной. Часть заправки выливают на салат в салатнице.
Грибной соус.
Поджарить в масле муку, пока она не станет светло-коричневой, развести ее при помешивании грибным бульоном и поварить 20 мин. Поджарить мелко нарезанный лук. Незадолго до окончания жарения добавить в него измельченные вареные грибы. Для приготовления соуса используют сушеные белые грибы или свежие шампиньоны. Соединить соус с луком и грибами, посолить, добавить лавровый лист, перец и вскипятить.
Пропорция: 2 стакана грибного бульона, 2 столовые ложки сливочного масла, 1 столовая ложка муки, 1 луковица, 200 г сушеных грибов.
Основной грибной соус (болгарское блюдо).
Его готовят на бульоне из грибов, лучше сушеных. Основной грибной соус используют для мясных и овощных блюд. Стакан сушеных грибов сварить в 0,5 л воды и процедить. В трех ложках топленого масла вместе с мелко нарезанными грибами потушить 3-4 головки мелко нарезанного лука. Отдельно обжарить в ложке масла ложку муки; развести ее в 1/4 стакана грибного бульона и поварить 15-20 мин. После этого в соус добавляют 1 жареный лук и грибы, варят 10-15 мин, солят, кладут черный перец и ложку сливочного масла и хорошенько перемешивают.
Соус бешемель с грибами (болгарское блюдо).
Разогреть 2-3 столовые ложки масла, прибавить 2-3 столовые ложки муки, поджарить до светло-золотистого цвета, постепенно разводя 1,5 стакана молока и помешивая, чтобы получилась густая однородная масса. Затем влить еще 1/2 стакана молока, в которое предварительно разбить два желтка, добавить стакан бульона, соль по вкусу и, держа на огне, помешивать. Когда соус закипит, его снимают с огня и добавляют еще 1/2 стакана молока. В готовый соус кладут блюдечко вычищенных, вымытых и мелко нарезанных свежих грибов, и все это варят на слабом огне 15 мин. Затем снимают с огня и добавляют ложку сливочного масла. Соус подают к вареным цыплятам, мозгам, яйцам и др.
Грибной соус.
Вымыть в холодной воде и сварить 11/2 стакана свежих шампиньонов; 3-4 головки мелко нарезанного лука потушить в 2 ложках сливочного масла до мягкости, добавить мелко нарезанные вареные грибы и потушить еще 10 мин. В ложке масла отдельно поджарить до золотистого цвета неполную столовую ложку муки, добавить 2 стакана грибного бульона и варить около 10 мин. Потом смешать полученный соус с жареным луком и грибами и варить еще 10 мин, в почти готовый соус добавить соль и черный перец.
Начинка из грибов.
Грибы промыть, очистить и отварить в подсоленной воде до готовности. Сухие грибы предварительно замочить на 3 ч в холодной воде, воду слить, налить свежую и отварить в ней грибы. Сваренные грибы пропустить через мясорубку или мелко изрубить и обжарить в 1 столовой ложке жира. Из жира, муки и лука приготовить соус. Для этого надо нагреть жир, пока не исчезнет пена и не прекратится шипение, положить мелко нарезанный лук и, помешивая, обжарить его до ровной золотистой окраски. Затем добавить муку, обжарить ее до светло-коричневого цвета, разбавить бульоном или водой до консистенции густой сметаны, и, помешивая, варить 10мин, после чего добавить перец, лавровый лист, зелень, соль и по желанию сметану. Готовый соус смешивают с грибами. Можно приготовить начинку из половинной нормы грибов и 1 стакана квашеной капусты.
Пропорция: 400 г свежих или 100 г сухих грибов, 1 луковица, 1 чайная ложка пшеничной муки, 2 столовые ложки жира, соль, перец, зелень по вкусу, 1/2 стакана бульона или воды.
Пирожки со сморчками (узбекское блюдо).
Из несладкого пирожкового теста на соде сформовать круглые лепешки. Сморчки перебрать, промыть, дважды прокипятить в большом количестве подсоленной воды, откинуть на дуршлаг и, когда вода стечет, нарезать мелкими кусочками. Мелко нарезанное мясо положить в кипящий жир, туда же добавить сморчки, соль, перец, мелко нарезанную зелень и жарить до выпаривания влаги. Пирожки с начинкой сформовать треугольной формы, обмакнуть в простоквашу и выпекать в тындыре или на противне, уложив их швом вниз. После выпечки смазать маслом.
Пропорция: для теста — 2 стакана муки; для начинки — 200 г свежих грибов, 100 г масла или маргарина, 160 г мякоти баранины, 1 головка репчатого лука, 5 г кинзы или укропа, перец, соль, 1 стакан простокваши.
Томатный соус с грибами (старинное русское блюдо).
Мелко нашинкованный лук пассеровать на растительном масле. Пассерованный лук и нарезанные тонкими кусочками шампиньоны или белые свежие грибы соединить с томатным соусом и варить 10-15 мин, после чего в соус добавить мелко нарубленный чеснок и соль.
Пропорция: 900 г томатного соуса, 150 г грибов, 100 г лука репчатого, 15 г подсолнечного масла, 5 г чеснока.
Луковый соус с грибами (русское блюдо).
В мелко нарубленный пассерованный репчатый лук добавить вареные рубленые белые грибы или шампиньоны, перец горошком, лавровый лист и все вместе пассеровать 5-6 мин. Затем влить белое вино, уварить его на Уз, соединить с красным основным соусом, положить соль и варить 10-15 мин при слабом кипении. Заправить соус сливочным маслом.
Пропорция: 800 г красного основного соуса, 45 г маргарина, 30 г сливочного масла, 300 г лука репчатого, 5 г сахарного песка, 75 г 9%-ного уксуса, 0,5 г перца горошком, 0,2 г лаврового листа.
Красный основной соус готовят так. Варят коричневый бульон из обжаренных мясных костей и процеживают его. Часть бульона (1/5) сливают в отдельную посуду, охлаждают до 50°С, всыпают просеянную, слегка обжаренную без жира пшеничную муку и размешивают до однородной массы. В остальной бульон кладут слегка обжаренные с томатом-пюре коренья и лук, нагревают до кипения, затем вливают бульон, смешанный с мукой, снова размешивают и, периодически помешивая, варят при слабом кипении в течение 1 ч. По окончании варки добавляют сахар, соус подкрашивают жженым сахаром и процеживают; оставшиеся на сите овощи протирают и соединяют с соусом.
Пропорция: 1 л бульона, 3! г маргарина, 80 г моркови, 20 г корня петрушки, 40 г лука репчатого, 50 г пшеничной муки, 200 г томата-пюре, 25 г сахара, из них 5 г на жженый.
Пудинг из сушеных грибов.
Грибы тщательно промыть, отварить, процедить. Форму для пудинга смазать маслом и посыпать сухарями. Вымочить в молоке и отжать булку. Лук нарезать кружками, поджарить до светло-золотистого цвета. Грибы, булку и лук пропустить через мясорубку. Перетереть жир с желтками, добавить грибную массу, заправить по вкусу солью и перцем. Белки взбить, смешать с грибной массой, выложить в форму для пудинга, плотно прикрыть ее крышкой и варить на пару 45 мин. Грибной пудинг подавать с грибным соусом, приготовленным из оставшегося грибного бульона, или со сливочным маслом. Хорошо приготовленный пудинг должен быть слегка подрумяненным, иметь вид пышной бабки, легко резаться.
Пропорция: 40-60 г сушеных грибов, 50 г лука, 50 г жира, 4 яйца, 100 г черствой булки, около 1/8 л молока, соль, перец, 20 г масла для формы, 20 г сухарей для формы.
Пирог с грибами.
Муку размешать с подогретым жиром, после чего добавить воду. Хорошо замешанному тесту дать затвердеть на холоде. Нарезанные грибы и лук слегка подрумянить. Тесто раскатать на две не совсем одинаковые части, из которых большая будет нижней корочкой пирога. Грибы с луком ровным слоем разложить на нижней корочке, закрыть верхней и загнуть края нижней корочки на верхнюю. Прирог смазать взбитым яйцом и выпекать 20-30 мин при температуре 225°С.
Пропорция: 250 г маргарина или сливочного масла, 250 г пшеничной муки, 0,75 л воды, 500 г грибов, 2 луковицы, соль и специи по вкусу.
Салат из шампиньонов (венгерское блюдо).
Сварить грибы, откинуть на сито и, когда вода стечет, нарезать ломтиками. Приготовить густой соус из растительного масла, уксуса или лимонного сока, растопленного желатина, посолить его и поперчить по вкусу. Перед подачей на стол смешать грибы с соусом.
Пропорция: 300 г шампиньонов, 3- 4 столовые ложки растительного масла, 2 столовые ложки уксуса или лимонного сока, 1 чайная ложка сахарного песка, 1 столовая ложка растопленного желатина, соль, перец.
Соус из сухих грибов (старинное русское блюдо).
Взять 100 г мелких сухих грибов, промыть их в кипятке, залить 3-3 1/2 стаканами холодной воды и поставить варить. Когда грибы будут достаточно мягкими, в кастрюле пассеруют 1/2 ложки муки в ложке масла, разводят ее процеженным грибным наваром до желаемой густоты, а затем, добавив в соус мелко нашинкованные в длину отваренные грибы, соль, сахар и уксус по вкусу, дают ему прокипеть.
Пропорция: 100 г сухих грибов, 3- 3 1/2 стакана воды, соль, сахар по вкусу, 1 чайная ложка уксуса.
Прежде чем обрабатывать грибы, их необходимо тщательно рассортировать по видам
Салат с вешенкой обыкновенной и картофелем.
Для него необходимы 300 г соленых, маринованных или обжаренных плодовых тел вешенки обыкновенной, 200 г отварного картофеля, 1 огурец, 1 луковица, 200-300 г сметаны, соль, сахар, горчица. Продукты нарезают красивыми ровными дольками и смешивают с заправленной сметаной.
Салат из грибов (болгарское блюдо).
0,5 кг грибов хорошо вымыть и прокипятить в соленой воде 10-15 мин вместе с несколькими зернышками черного перца и 2-3 лавровыми листьями. Затем грибы откинуть на сито, дать стечь отвару, нарезать и положить в маринад, приготовленный из неполной кофейной чашки уксуса, небольшого количества соли, кофейной чашки растительного масла, 5-6 долек измельченного чеснока и пучка мелко нарезанной петрушки. Смесь слегка размешать и через 10-15 мин подать к столу.
Салат из грибов и яиц (старинное русское блюдо).
Около 1 кг грибов чистят, хорошо промывают, варят в подсоленной воде и откидывают на сито, чтобы стекла вода. Растирают с черным перцем 5 сваренных вкрутую желтков, добавляют 80 г растительного масла, сок целого лимона или 1/2 стакана уксуса, все размешивают и заливают этой смесью грибы, слегка помешивая. Готовое блюдо перед подачей на стол посыпают петрушкой.
Грибной салат с ветчиной (финское блюдо).
Для него берут 200 г соленых, маринованных или отварных грибов, 200 г ветчины, 200 г отварного картофеля, 1 соленый огурец и 1 луковицу, 200-300 г сметаны, столовый уксус, соль, сахар, горчицу. Продукты нарезают ровными дольками и смешивают с заправленной сметаной. Часть заправки выливают на салат в салатнице.
Грибной соус.
Поджарить в масле муку, пока она не станет светло-коричневой, развести ее при помешивании грибным бульоном и поварить 20 мин. Поджарить мелко нарезанный лук. Незадолго до окончания жарения добавить в него измельченные вареные грибы. Для приготовления соуса используют сушеные белые грибы или свежие шампиньоны. Соединить соус с луком и грибами, посолить, добавить лавровый лист, перец и вскипятить.
Пропорция: 2 стакана грибного бульона, 2 столовые ложки сливочного масла, 1 столовая ложка муки, 1 луковица, 200 г сушеных грибов.
Основной грибной соус (болгарское блюдо).
Его готовят на бульоне из грибов, лучше сушеных. Основной грибной соус используют для мясных и овощных блюд. Стакан сушеных грибов сварить в 0,5 л воды и процедить. В трех ложках топленого масла вместе с мелко нарезанными грибами потушить 3-4 головки мелко нарезанного лука. Отдельно обжарить в ложке масла ложку муки; развести ее в 1/4 стакана грибного бульона и поварить 15-20 мин. После этого в соус добавляют 1 жареный лук и грибы, варят 10-15 мин, солят, кладут черный перец и ложку сливочного масла и хорошенько перемешивают.
Соус бешемель с грибами (болгарское блюдо).
Разогреть 2-3 столовые ложки масла, прибавить 2-3 столовые ложки муки, поджарить до светло-золотистого цвета, постепенно разводя 1,5 стакана молока и помешивая, чтобы получилась густая однородная масса. Затем влить еще 1/2 стакана молока, в которое предварительно разбить два желтка, добавить стакан бульона, соль по вкусу и, держа на огне, помешивать. Когда соус закипит, его снимают с огня и добавляют еще 1/2 стакана молока. В готовый соус кладут блюдечко вычищенных, вымытых и мелко нарезанных свежих грибов, и все это варят на слабом огне 15 мин. Затем снимают с огня и добавляют ложку сливочного масла. Соус подают к вареным цыплятам, мозгам, яйцам и др.
Грибной соус.
Вымыть в холодной воде и сварить 11/2 стакана свежих шампиньонов; 3-4 головки мелко нарезанного лука потушить в 2 ложках сливочного масла до мягкости, добавить мелко нарезанные вареные грибы и потушить еще 10 мин. В ложке масла отдельно поджарить до золотистого цвета неполную столовую ложку муки, добавить 2 стакана грибного бульона и варить около 10 мин. Потом смешать полученный соус с жареным луком и грибами и варить еще 10 мин, в почти готовый соус добавить соль и черный перец.
Начинка из грибов.
Грибы промыть, очистить и отварить в подсоленной воде до готовности. Сухие грибы предварительно замочить на 3 ч в холодной воде, воду слить, налить свежую и отварить в ней грибы. Сваренные грибы пропустить через мясорубку или мелко изрубить и обжарить в 1 столовой ложке жира. Из жира, муки и лука приготовить соус. Для этого надо нагреть жир, пока не исчезнет пена и не прекратится шипение, положить мелко нарезанный лук и, помешивая, обжарить его до ровной золотистой окраски. Затем добавить муку, обжарить ее до светло-коричневого цвета, разбавить бульоном или водой до консистенции густой сметаны, и, помешивая, варить 10мин, после чего добавить перец, лавровый лист, зелень, соль и по желанию сметану. Готовый соус смешивают с грибами. Можно приготовить начинку из половинной нормы грибов и 1 стакана квашеной капусты.
Пропорция: 400 г свежих или 100 г сухих грибов, 1 луковица, 1 чайная ложка пшеничной муки, 2 столовые ложки жира, соль, перец, зелень по вкусу, 1/2 стакана бульона или воды.
Пирожки со сморчками (узбекское блюдо).
Из несладкого пирожкового теста на соде сформовать круглые лепешки. Сморчки перебрать, промыть, дважды прокипятить в большом количестве подсоленной воды, откинуть на дуршлаг и, когда вода стечет, нарезать мелкими кусочками. Мелко нарезанное мясо положить в кипящий жир, туда же добавить сморчки, соль, перец, мелко нарезанную зелень и жарить до выпаривания влаги. Пирожки с начинкой сформовать треугольной формы, обмакнуть в простоквашу и выпекать в тындыре или на противне, уложив их швом вниз. После выпечки смазать маслом.
Пропорция: для теста — 2 стакана муки; для начинки — 200 г свежих грибов, 100 г масла или маргарина, 160 г мякоти баранины, 1 головка репчатого лука, 5 г кинзы или укропа, перец, соль, 1 стакан простокваши.
Томатный соус с грибами (старинное русское блюдо).
Мелко нашинкованный лук пассеровать на растительном масле. Пассерованный лук и нарезанные тонкими кусочками шампиньоны или белые свежие грибы соединить с томатным соусом и варить 10-15 мин, после чего в соус добавить мелко нарубленный чеснок и соль.
Пропорция: 900 г томатного соуса, 150 г грибов, 100 г лука репчатого, 15 г подсолнечного масла, 5 г чеснока.
Луковый соус с грибами (русское блюдо).
В мелко нарубленный пассерованный репчатый лук добавить вареные рубленые белые грибы или шампиньоны, перец горошком, лавровый лист и все вместе пассеровать 5-6 мин. Затем влить белое вино, уварить его на Уз, соединить с красным основным соусом, положить соль и варить 10-15 мин при слабом кипении. Заправить соус сливочным маслом.
Пропорция: 800 г красного основного соуса, 45 г маргарина, 30 г сливочного масла, 300 г лука репчатого, 5 г сахарного песка, 75 г 9%-ного уксуса, 0,5 г перца горошком, 0,2 г лаврового листа.
Красный основной соус готовят так. Варят коричневый бульон из обжаренных мясных костей и процеживают его. Часть бульона (1/5) сливают в отдельную посуду, охлаждают до 50°С, всыпают просеянную, слегка обжаренную без жира пшеничную муку и размешивают до однородной массы. В остальной бульон кладут слегка обжаренные с томатом-пюре коренья и лук, нагревают до кипения, затем вливают бульон, смешанный с мукой, снова размешивают и, периодически помешивая, варят при слабом кипении в течение 1 ч. По окончании варки добавляют сахар, соус подкрашивают жженым сахаром и процеживают; оставшиеся на сите овощи протирают и соединяют с соусом.
Пропорция: 1 л бульона, 3! г маргарина, 80 г моркови, 20 г корня петрушки, 40 г лука репчатого, 50 г пшеничной муки, 200 г томата-пюре, 25 г сахара, из них 5 г на жженый.
Пудинг из сушеных грибов.
Грибы тщательно промыть, отварить, процедить. Форму для пудинга смазать маслом и посыпать сухарями. Вымочить в молоке и отжать булку. Лук нарезать кружками, поджарить до светло-золотистого цвета. Грибы, булку и лук пропустить через мясорубку. Перетереть жир с желтками, добавить грибную массу, заправить по вкусу солью и перцем. Белки взбить, смешать с грибной массой, выложить в форму для пудинга, плотно прикрыть ее крышкой и варить на пару 45 мин. Грибной пудинг подавать с грибным соусом, приготовленным из оставшегося грибного бульона, или со сливочным маслом. Хорошо приготовленный пудинг должен быть слегка подрумяненным, иметь вид пышной бабки, легко резаться.
Пропорция: 40-60 г сушеных грибов, 50 г лука, 50 г жира, 4 яйца, 100 г черствой булки, около 1/8 л молока, соль, перец, 20 г масла для формы, 20 г сухарей для формы.
Пирог с грибами.
Муку размешать с подогретым жиром, после чего добавить воду. Хорошо замешанному тесту дать затвердеть на холоде. Нарезанные грибы и лук слегка подрумянить. Тесто раскатать на две не совсем одинаковые части, из которых большая будет нижней корочкой пирога. Грибы с луком ровным слоем разложить на нижней корочке, закрыть верхней и загнуть края нижней корочки на верхнюю. Прирог смазать взбитым яйцом и выпекать 20-30 мин при температуре 225°С.
Пропорция: 250 г маргарина или сливочного масла, 250 г пшеничной муки, 0,75 л воды, 500 г грибов, 2 луковицы, соль и специи по вкусу.
Салат из шампиньонов (венгерское блюдо).
Сварить грибы, откинуть на сито и, когда вода стечет, нарезать ломтиками. Приготовить густой соус из растительного масла, уксуса или лимонного сока, растопленного желатина, посолить его и поперчить по вкусу. Перед подачей на стол смешать грибы с соусом.
Пропорция: 300 г шампиньонов, 3- 4 столовые ложки растительного масла, 2 столовые ложки уксуса или лимонного сока, 1 чайная ложка сахарного песка, 1 столовая ложка растопленного желатина, соль, перец.
Соус из сухих грибов (старинное русское блюдо).
Взять 100 г мелких сухих грибов, промыть их в кипятке, залить 3-3 1/2 стаканами холодной воды и поставить варить. Когда грибы будут достаточно мягкими, в кастрюле пассеруют 1/2 ложки муки в ложке масла, разводят ее процеженным грибным наваром до желаемой густоты, а затем, добавив в соус мелко нашинкованные в длину отваренные грибы, соль, сахар и уксус по вкусу, дают ему прокипеть.
Пропорция: 100 г сухих грибов, 3- 3 1/2 стакана воды, соль, сахар по вкусу, 1 чайная ложка уксуса.
Последние комментарии
1 день 20 часов назад
2 дней 4 часов назад
2 дней 4 часов назад
2 дней 6 часов назад
2 дней 9 часов назад
2 дней 11 часов назад